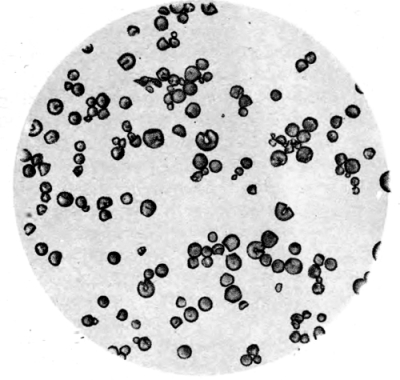

Figure 1. Mill for Grinding Dry Samples.
A MANUAL FOR THE EXAMINATION OF SOILS,
FERTILIZERS, AND AGRICULTURAL PRODUCTS.
FOR THE USE OF ANALYSTS, TEACHERS, AND
STUDENTS OF AGRICULTURAL CHEMISTRY.
VOLUME III.
AGRICULTURAL PRODUCTS.
BY HARVEY W. WILEY,
Chemist of the U. S. Department of Agriculture..
EASTON, PA.
Chemical Publishing Co.
1897.
COPYRIGHT, 1897,
By Harvey W. Wiley.
PREFACE TO VOLUME THIRD.
The concluding volume of the Principles and Practice of Agricultural Analysis has been written in harmony with the plan adopted at the commencement of the first volume. In it an effort has been made to place the analyst or student en rapport with all the best methods of studying the composition of agricultural products. During the progress of the work the author has frequently been asked why some special method in each case has not been designated as the proper one to be used. To do this would be a radical departure from the fundamental idea of the work; viz., to rely on the good judgment and experience of the chemist. It is not likely that the author’s judgment in such matters is better than that of the analyst using the book, and, except for beginning students pursuing a course of laboratory instruction, a biased judgment is little better than none at all. For student’s work in the laboratory or classroom it is probable that a volume of selected methods based on the present work may be prepared later on, but this possible future need has not been allowed to change the purpose of the author as expressed in the preface of the second volume “to present to the busy worker a broad view of a great subject.” For the courtesy and patience of the publishers, for the uniformly commendatory notices of the reviewers of volumes one and two, and for the personal encouraging expressions of his professional brethren the author is sincerely grateful. He finds in this cordial reception of his book a grateful compensation for long years of labor. The plates of the first edition of the three volumes have been destroyed in order to insure a re-writing of the second edition when it shall be demanded, in order to keep it abreast of the rapid progress in the field of agricultural chemical analysis.
Washington, D. C.,
Beginning of January, 1897.
PART FIRST.
SAMPLING, DRYING, INCINERATION
AND EXTRACTIONS.
Introduction, pp. 1-3.—Methods of study; Scope of the work; Limitations of work; General manipulations.
Methods of Sampling, pp. 3-13.—Vegetable substances; Animal substances; Preserving samples; Collecting samples; Grinding samples; Grinding apparatus.
Drying Organic Bodies, pp. 13-36.—Volatile bodies; Drying ovens; Air baths; Drying in vacuum; Electric drying ovens; Steam coil apparatus; Drying in hydrogen; Drying in tubes; Drying viscous liquids; General principles of drying.
Incineration, pp. 36-40.—Principles of incineration; Products of combustion; Purpose and conduct of incineration; German ash method; Courtonne’s muffle.
Extraction of Organic Bodies, pp. 40-57.—Object of extraction; Solvents; Methods of extraction; Extraction by digestion; Extraction by percolation; Apparatus for extraction; Knorr’s extraction apparatus; Soxhlet’s extraction apparatus; Compact extraction apparatus; Recovery of solvents; Authorities cited in Part First.
PART SECOND.
SUGARS AND STARCHES.
Introduction, pp. 58-62.—Carbohydrates; Nomenclature; Preparation of pure sugar; Classification of methods of analysis.
Analysis by Density of Solution, pp. 63-72.—Principles of the method; Pyknometers; Calculating volume of pyknometers; Hydrostatic balance; Areometric method; Correction for temperature; Brix hydrometer; Comparison of brix and baumé degrees; Errors due to impurities.
Estimation of Sugars with Polarized Light, pp. 74-120.—Optical properties of sugars; Polarized light; Nicol prism; Polariscope; Kinds of polariscopes; Character of light; Description of polarizing instruments: Laurent polariscope; Polariscope lamps; [Pg v] Soleil-Ventzke polariscope; Half Shadow polariscope; Triple field polariscope; Setting the polariscope; Control observation tube; Quartz plates; Correcting quartz plates; Application of quartz plates; Sugar flasks; Preparing sugar solutions for polarization; Alumina cream; Errors due to lead solutions; Double polarization; Mercuric compounds; Bone-black; Inversion of sugar; Clerget’s method; Influence of strength of solution; Calculation of results; Method of Lindet; Use of invertase; Activity of invertase; Inversion by yeast; Determination of sucrose; Determination of raffinose; Specific rotatory power; Calculating specific rotatory power; Variations in specific rotatory power; Gyrodynatic data; Birotation.
Chemical Methods of Estimating Sugar, pp. 120-149.—General principles; Classification of methods; Reduction of mercuric salts; Sachsse’s solution; Volumetric copper methods; Action of copper solution on dextrose; Fehling’s solution; List of copper solutions; Volumetric laboratory method; Filtering tubes; Correction of errors; Permanganate process; Modified permanganate method; Specific gravity of cuprous oxid; Soldaini’s process; Relation of reducing sugar to quantity of suboxid; Factors for different sugars; Pavy’s process; Peska’s process; Method of Allein and Gaud; Method of Gerrard; Sidersky’s modification; Titration of excess of copper.
Gravimetric Copper Methods, pp. 149-170.—General principles; Laboratory copper method; Halle method; Allihn’s method; Meissl’s method; Determination of invert sugar; Estimation of milk sugar; Determination of maltose; Preparation of levulose; Estimation of levulose.
Miscellaneous Methods of Sugar Analysis, pp. 171-196; Phenylhydrazin; Molecular weights of carbohydrates; Birotation; Estimation of pentosans; Determination of furfurol; Method of Tollens; Method of Stone; Method of Chalmot; Method of Krug; Precipitation with pyrogalol; Precipitation with phloroglucin; Fermentation methods; Estimating alcohol; Estimating carbon dioxid; Precipitation with earthy bases; Barium saccharate; Strontium saccharate; Calcium saccharate; Qualitive tests; Optical tests; Cobaltous nitrate test; The Dextrose group; Tests for levulose; Tests for galactose; Tests for invert sugar; Compounds with phenylhydrazin; Detection of sugars by means of furfurol; Bacterial action on sugars.
Determination of Starch, pp. 196-226.—Constitution of starch; Separation of starch; Methods of separation; Separation with diastase; Separation in an autoclave; Principles of analysis; Estimation of water; Estimation of ash; Estimation of nitrogen; Hydrolysis with acids; Factors for calculation; Polarization of starch; Solution at high pressure; Method of Hibbard; Precipitation with barium hydroxid; Disturbing bodies in starch determinations; Colorimetric estimation of starch; Fixation of iodin; Identification of starches; Vogel’s table; Muter’s table; Blyth’s classification; Preparation of starches for the microscope; Mounting in canada balsam; Description of typical starches; Authorities cited in Part Second. [Pg vi]
PART THIRD.
SEPARATION AND DETERMINATION
OF CARBOHYDRATES IN CRUDE OR
MANUFACTURED AGRICULTURAL PRODUCTS.
Sugars in Vegetable Juices, pp. 227-253.—Introduction; Sugar in the sap of trees; Sugar in sugar canes; Weighing pipettes; Gravimeter; Reducing sugars in juices; Preservation of juices; Direct estimation of sugar; Cutting or shredding canes; Methods of analysis; Drying and extracting; Examination of bagasse; Fiber in canes; Sugar beets; Estimation of sugar in sugar beets; Machines for pulping beets; Instantaneous diffusion; Pellet’s process; Alcohol digestion; Extraction with alcohol; Determination of sugar in mother beets; Determination of sugars without weighing; Continuous observation tube.
Analysis of Sirups and Massecuites, pp. 254-264.—Specific gravity; Determination of water; Determination of ash; Determination of reducing sugars; Estimation of minute quantities of invert sugar; Soldaini’s gravimetric method; Weighing the copper as oxid; Analyses for factory control.
Separation of Carbohydrates in Mixtures, pp. 264-292.—Occurrence of sugars; Optical methods; Optical neutrality of invert sugar; Separation of sucrose and invert sugar; Separation of sucrose and raffinose; Determination of levulose; Formula for calculating levulose; Separation of sucrose from dextrose; Estimation of lactose in milk; Error due to volume of precipitate; Separation of sucrose, levulose and dextrose; Sieben’s method; Wiechmann’s method; Copper carbonate method; Winter’s process; Separation with lead oxid; Analysis of commercial glucose and grape sugar; Fermentation method; Oxidation method; Removal of dextrose by copper acetate; Separation of dextrin with alcohol.
Carbohydrates in Milk, pp. 293-298.—Copper tartrate method; The official method; The copper cyanid process; Separation of sugars in evaporated milks; Method of Bigelow and McElroy.
Separation and Determination of Starch and Fiber, pp. 298-306.—Occurrence; Separation of starch; Dry amyliferous bodies; Indirect method of determining water; Removal of oils and sugars; Preparation of diastase; Estimation of starch in potatoes; Constitution of cellulose; Fiber in cellulose; Official method; Separation of cellulose: Solubility of cellulose; Qualitive reactions for cellulose; Rare carbohydrates; Authorities cited in Part Third. [Pg vii]
PART FOURTH.
FATS AND OILS.
General Principles, pp. 309-316.—Nomenclature; Composition; Principal glycerids; Presses for extraction; Solvents; Freeing extracts of petroleum; Freeing fats of moisture; Sampling and drying for analysis; Estimation of water.
Physical Properties of Fats and Oils, pp. 317-350.—Specific gravity; Balance for determining specific gravity; Expression of specific gravity; Coefficient of expansion of oils; Densities of common fats and oils; Melting point; Determination in capillary tube; Determination by spheroidal state; Solidifying point; Temperature of crystallization; Refractive power; Refractive index; Abbe’s refractometer; Pulfrich’s refractometer; Refractive indices of common oils; Oleorefractometer; Butyrorefractometer; Range of application of the butyrorefractometer; Viscosity; Torsion viscosimeter; Microscopic appearance; Preparation of fat crystals; Observation of fat crystals with polarized light; Spectroscopic examination of oils; Critical temperature; Polarization; Turbidity temperature.
Chemical Properties of Fats and Oils, pp. 351-406.—Solubility in alcohol; Coloration produced by oxidants; Nitric acid coloration; Phosphomolybdic acid coloration; Picric acid coloration; Silver nitrate coloration; Stannic bromid coloration; Auric chlorid coloration; Thermal reactions; Heat of sulfuric saponification; Maumené’s process; Method of Richmond; Relative maumené figure; Heat of bromination; Method of Hehner and Mitchell; Author’s method; Haloid addition numbers; Hübl number; Character of chemical reaction; Solution in carbon tetrachlorid; Estimation of the iodin number; Use of iodin monochlorid; Preservation of the hübl reagent; Bromin addition number; Method of Hehner; Halogen absorption by fat acids; Saponification; Saponification in an open dish; Saponification under pressure; Saponification in the cold; Saponification value; Saponification equivalent; Acetyl value; Determination of volatile fat acids; Removal of the alcohol; Determination of soluble and insoluble fat acids; Formulas for calculation; Determination of free fat acids; Identification of oils and fats; Nature of fat acids; Separation of glycerids; Separation with lime; Separation with lead salts; Separation of arachidic acid; Detection of peanut oil; Bechi’s test; Milliau’s test; Detection of sesamé oil; Sulfur chlorid reaction; Detection of cholesterin and phytosterin; Absorption of oxygen; Elaidin reactions; Authorities cited in Part Fourth.
PART FIFTH.
SEPARATION AND ESTIMATION OF BODIES
CONTAINING NITROGEN.
Introduction and Definitions, pp. 410-418.—Nature of nitrogenous bodies; Classification of proteids; Albuminoids; Other forms of nitrogen; Occurrence of nitrates.
Qualitive Tests for Nitrogenous Bodies, pp. 418-422.—Nitric acid; Amid nitrogen; Ammoniacal nitrogen; Proteid [Pg viii] nitrogen; Qualitive tests for albumni; Qualitive tests for peptones and albuminates; Action of polarized light on albumins; Alkaloidal nitrogen.
Estimation of Nitrogenous Bodies in Agricultural Products, pp. 423-432.—Total nitrogen; Ammoniacal nitrogen; Amid nitrogen; Sachsse’s method; Preparation of asparagin; Estimation of asparagin and glutamin; Cholin and betain; Lecithin; Factors for calculating results; Estimation of alkaloidal nitrogen.
Separation of Proteid Bodies in Vegetable Products, pp. 432-448.—Preliminary treatment; Character of proteids; Separation of gluten; Extraction with water; Action of water on composition of proteids; Extraction with dilute salt solution; Separation of bodies soluble in water; Separation of the globulins; Proteids soluble in dilute alcohol; Solvent action of acids and alkalies; Method of extraction; Methods of drying separated proteids; Determination of ash; Determination of carbon and hydrogen; Estimation of nitrogen; Determination of sulfur; Dialysis.
Separation and Estimation of Nitrogenous Bodies in Animal Products, pp. 448-462.—Preparation of sample; Extraction of muscular tissues; Composition of meat extracts; Analysis of meat extracts; Use of phosphotungstic acid; Separation of albumoses and peptones; Estimation of gelatin; Estimation of nitrogen in flesh bases; Treatment of residue insoluble in alcohol; Pancreas peptone; Albumose peptone; Authorities cited in Part Fifth.
PART SIXTH.
DAIRY PRODUCTS.
Milk, pp. 464-512.—Composition of milk; Alterability of milk; Effects of boiling on milk; Micro-organisms of milk; Sampling milk; Scovell’s milk sampler; Preserving milk for analysis; Freezing point; Electric conductivity; Viscosity; Acidity and alkalinity; Determination of acidity; Opacity; Creamometry; Specific gravity; Lactometry; Quévenne lactometer; Lactometer of the New York Board of Health; Density of sour milk; Density of milk serum; Total solids; Formulas for calculating total solids; Determination of ash; Estimation of fat; Fat globules; Number of fat globules; Counting globules; Classification of methods of analysis; Dry extraction methods; Official methods; Variations of extraction methods; Gypsum method; Estimation of fat in malted milk; Comparison of fat methods; Wet extraction methods; Solution in acid; Solution in alkali; Method of Short; Method of Thörner; Liebermann’s method; Densimetric methods; Areometric methods; Lactobutyrometer; Volumetric methods of fat analysis; Method of Patrick; The lactocrite; Modification of Lindström; Babcock’s method; Method of Leffmann and Beam; Method of Gerber; Proteid bodies in milk; Estimation of total [Pg ix] proteid matter; Copper sulfate as a reagent; Precipitation by ammonium sulfate; Precipitation by tannic acid; Separation of casein from albumin; Estimation of casein; Factors for calculation; Separation of casein; Separation of casein with carbon dioxid; Separation of albumin; Separation of globulin; Precipitants of milk proteids; Precipitation by dialysis; Carbohydrates in milk; Dextrinoid body in milk; Amyloid bodies in milk.
Butter, pp. 512-523.—General principles of analysis; Appearance of melted butter; Microscopic examination; Refractive power; Estimation of water, fat, casein, ash and salt; Volatile and soluble acids; Relative proportion of glycerids; Saponification value; Reichert number; Reichert-Meissl method; Elimination of sulfurous acid; Errors due to poor glass; Molecular weight of butter; Substitutes for and adulterants of butter; Butter colors.
Cheese and Koumiss, pp. 524-536.—Composition of cheese; Manufacture of cheese; Official methods of analysis; Process of Mueller; Separation of fat from cheese; Filled cheese; Separation of nitrogenous bodies; Preparation of koumiss; Determination of carbon dioxid; Acidity; Estimation of alcohol; Proteids in koumiss; Separation by porous porcelain; Separation by precipitation with alum; Separation with mercury salts; Determination of water and ash; Composition of koumiss; Authorities cited in Part Sixth.
PART SEVENTH.
MISCELLANEOUS AGRICULTURAL PRODUCTS.
Cereals and Cereal Foods, pp. 541-545.— Classification; General methods of analysis; Composition and analysis of bread; Determination of alum in bread; Chemical changes produced by baking.
Fodders, Grasses, and Ensilage, pp. 545-547.—General principles of analysis; Organic acids in ensilage; Changes due to fermentation; Alcohol in ensilage; Comparative values of dry fodder and ensilage.
Flesh Products, pp. 547-555.—Names of meats; Sampling; General methods of analysis; Examination of nitrogenous bodies; Fractional analysis of meats; Starch in meats; Detection of horse flesh.
Methods of Digestion, pp. 555-564.—Artificial digestion; Amylolytic ferments; Aliphalytic ferments; Proteolytic ferments; Pepsin and pancreatin; Digestion in pancreas extract; Artificial digestion of cheese; Natural digestion; Digestibility of pentosans.
Preserved Meats, pp. 565-566.—Methods of examination; Estimation of fat; Meat preservatives.
Determination of Nutritive Values, pp. 566-576.—Nutritive value of foods; Comparative value of food constituents; Nutritive ratio; Calorimetric analysis of foods; Combustion in oxygen; Bomb calorimeter; Manipulation and calculation; Computing the calories of combustion; Calorimetric equivalents; Distinction between butter and oleomargarin. [Pg x]
Fruits, Melons and Vegetables, pp. 577-582.— Preparation of samples; Separation of carbohydrates; Examination of the fresh matter; Examination of fruit and vegetable juices; Separation of pectin; Determination of free acid; Composition of fruits; Composition of ash of fruits; Dried fruits; Zinc in evaporated fruits; Composition of melons.
Tea and Coffee, pp. 582-588.—Special points in analysis; Estimation of caffein; Iodin method; Spencer’s method; Separation of chlorophyll; Determination of proteid nitrogen; Carbohydrates of coffee; Estimation of galactan; Revised factors for pentosans; Use of roentgen rays.
Tannins and Allied Bodies, pp. 588-596.— Occurrence and composition; Detection and estimation; Precipitation with metallic salts; The gelatin method; The hide powder method; Permanganate gelatin method; Permanganate hide powder method; Preparation of infusion.
Tobacco, pp. 596-610.—Fermented and unfermented tobacco; Acid and basic constituents; Composition of ash; Composition of tobacco; Estimation of water; Estimation of nitric acid; Estimation of sulfuric and hydrochloric acids; Estimation of oxalic, malic and citric acids; Estimation of acetic acid; Estimation of pectic acid; Estimation of tannic acid; Estimation of starch and sugar; Estimation of ammonia; Estimation of nicotin; Polarization method of Popovici; Estimation of amid nitrogen; Fractional extraction; Burning qualities; Artificial smoker.
Fermented Beverages, pp. 610-641.— Description; Important constituents; Specific gravity; Determination of alcohol; Distilling apparatus; Specific gravity of the distillate; Hydrostatic plummet; Calculating results; Table giving percentage of alcohol by weight and volume; Determination of percentage of alcohol by means of vapor temperature; Improved ebullioscope; Indirect determination of extract; Determination of total acids; Determination in a vacuum; Estimation of water; Total acidity; Volatile acids; Tartaric acid; Tartaric, malic and succinic acids; Polarizing bodies in fermented beverages; Reducing sugars; Polarization of wines and beers; Application of analytical methods; Estimation of carbohydrates; Determination of glycerol; Coloring matters; Determination of ash; Determination of potash; Sulfurous acid; Salicylic acid; Detection of gum and dextrin; Determination of nitrogen; Substitutes for hops; Bouquet of fermented and distilled liquors; Authorities cited in Part Seventh; Index.
| Page. | |||||
| Figure | 1. | Mill for grinding dry samples | 7 | ||
| ” | 2. | Comminutor for green samples | 9 | ||
| ” | 3. | Rasp for sugar beets | 10 | ||
| ” | 4. | Dreef grinding apparatus | 11 | ||
| ” | 5. | Water jacket drying oven | 14 | ||
| ” | 6. | Thermostat for Steam-Bath | 15 | ||
| ” | 7. | Spencer’s drying oven | 17 | ||
| ” | 8. | Electric vacuum drying oven | 19 | ||
| ” | 9. | Steam coil drying oven | 21 | ||
| ” | 10. | Carr’s vacuum drying oven | 22 | ||
| ” | 10. | (Bis.) vacuum oven open | 23 | ||
| ” | 11. | Apparatus for drying in a current of hydrogen | 25 | ||
| ” | 12. | Caldwell’s hydrogen drying apparatus | 27 | ||
| ” | 13. | Liebig’s ente | 28 | ||
| ” | 14. | Drying apparatus used at the Halle Station | 29 | ||
| ” | 15. | Wrampelmayer’s oven | 30 | ||
| ” | 16. | Ulsch drying oven | 31 | ||
| ” | 17. | Courtoune muffle | 39 | ||
| ” | 18. | Knorr’s extraction apparatus | 45 | ||
| ” | 19. | Extraction flask | 46 | ||
| ” | 20. | Extraction tube | 46 | ||
| ” | 21. | Extraction siphon tube | 46 | ||
| ” | 22. | Soxhlet extraction apparatus | 48 | ||
| ” | 23. | Compact condensing apparatus | 49 | ||
| ” | 24. | Improved compact extraction apparatus | 51 | ||
| ” | 25. | Knorr’s apparatus for recovering solvents | 54 | ||
| ” | 26. | Apparatus for recovering solvents from open dishes | 55 | ||
| ” | 27. | Common forms of pyknometers | 63 | ||
| ” | 28. | Bath for pyknometers | 66 | ||
| ” | 29. | Aereometers, pyknometers and hydrostatic balance | 68 | ||
| ” | 30. | Hydrostatic balance | 69 | ||
| ” | 31. | Course of rays of light in a nicol | 77 | ||
| ” | 32. | Theory of the nicol | 78 | ||
| ” | 33. | Laurent lamp | 83 | ||
| ” | 34. | Lamp for producing constant monochromatic flame | 85 | ||
| ” | 35. | Field of vision of a Laurent polariscope | 86 | ||
| ” | 36. | Laurent polariscope | 88 | ||
| ” | 37. | Tint polariscope | 89 | ||
| ” | 38. | Double compensating shadow polariscope | 91 | ||
| ” | 39. | Triple shadow polariscope | 92 | ||
| ” | 40. | Apparatus for producing a triple shadow | 92 | ||
| ” | 41. | Control observation tube | 95 | ||
| ” | 42. | Apparatus for the volumetric estimation | |||
| of reducing sugars | 131 | ||||
| ” | 43. | Apparatus for the electrolytic deposition of copper | 151 | ||
| ” | 44. | Apparatus for filtering copper suboxid | 154 | ||
| ” | 45. | Apparatus for reducing copper suboxid | 154 | ||
| ” | 46. | Distilling apparatus for pentoses | 179 | ||
| ” | 47. | Autoclave for starch analysis | 199 | ||
| ” | 47. | (Bis). Maercker’s hydrolyzing apparatus for starch | 204 | ||
| ” | 48. | Maranta starch | × 350 | to face | 220 |
| ” | 49. | Potato starch | × 350 | ||
| ” | 50. | Ginger starch | × 350 | ||
| ” | 51. | Sago starch | × 350 | ||
| ” | 52. | Pea starch | × 350 | ||
| ” | 53. | Bean starch | × 350 | ||
| ” | 54. | Wheat starch | × 350 | ||
| ” | 55. | Barley starch | × 350 | ||
| ” | 56. | Rye starch | × 350 | ||
| ” | 57. | Oat starch | × 350 | ||
| ” | 58. | Indian corn starch | × 350 | ||
| ” | 59. | Rice starch | × 350 | ||
| ” | 60. | Cassava starch | × 150 | ||
| ” | 61. | Indian corn starch | × 150 [Pg xii] | ||
| ” | 62. | Laboratory cane mill | 230 | ||
| ” | 63. | Weighing pipette | 231 | ||
| ” | 64. | Gird’s gravimeter | 233 | ||
| ” | 65. | Machine for cutting canes | 236 | ||
| ” | 66. | Cane cutting mill | 237 | ||
| ” | 67. | Apparatus for pulping beets | 243 | ||
| ” | 68. | Apparatus for cold diffusion | 245 | ||
| ” | 69. | Sickel-Soxhlet extractor | 247 | ||
| ” | 70. | Scheibler’s extraction tube | 248 | ||
| ” | 71. | Battery for alcoholic digestion | 250 | ||
| ” | 72. | Rasp for sampling mother beets | 251 | ||
| ” | 73. | Hand press for beet analysis | 251 | ||
| ” | 74. | Perforating rasp | 252 | ||
| ” | 75. | Tube for continuous observation | 253 | ||
| ” | 75. | (Bis). Chandler and Rickett’s Polariscope | 266 | ||
| ” | 76. | Apparatus for polarimetric observations | |||
| at low temperatures | 267 | ||||
| ” | 77. | Construction of desiccating tube | 268 | ||
| ” | 78. | Apparatus for polarizing at high temperatures | 269 | ||
| ” | 79. | Oil press | 312 | ||
| ” | 80. | Apparatus for fractional distillation | |||
| of petroleum ether | 314 | ||||
| ” | 81. | Section showing construction of a funnel | |||
| for hot filtration | 316 | ||||
| ” | 82. | Balance and Westphal sinker | 318 | ||
| ” | 83. | Melting point tubes | 322 | ||
| ” | 84. | Apparatus for the determination of melting point | 324 | ||
| ” | 85. | Apparatus for determining crystallizing point | 327 | ||
| ” | 86. | Abbe’s refractometer | 329 | ||
| ” | 87. | Charging position of refractometer | 330 | ||
| ” | 88. | Prism of Pulfrich’s refractometer | 331 | ||
| ” | 89. | Pulfrich’s new refractometer | 332 | ||
| ” | 90. | Heating apparatus for Pulfrich’s refractometer | 333 | ||
| ” | 91. | Spectrometer attachment | 333 | ||
| ” | 92. | Oleorefractometer | 335 | ||
| ” | 93. | Section showing construction of oleorefractometer | 335 | ||
| ” | 94. | Butyrorefractometer | 339 | ||
| ” | 95. | Doolittle’s viscosimeter | 343 | ||
| ” | 96. | Lard crystals | × 65 | to face | 348 |
| ” | 97. | Refined lard crystals | × 65 | ||
| ” | 98. | Apparatus for determining rise of temperature | |||
| with sulfuric acid | 358 | ||||
| ” | 99. | Apparatus for determining heat of bromination | 362 | ||
| ” | 100. | Olein tube | 374 | ||
| ” | 101. | Apparatus for saponifying under pressure | 380 | ||
| ” | 102. | Apparatus for the distillation of volatile acids | 388 | ||
| ” | 103. | Apparatus for amid nitrogen | 425 | ||
| ” | 104. | Sachsse’s eudiometer | 425 | ||
| ” | 105. | Dialyzing apparatus | 447 | ||
| ” | 106. | Scovell’s milk sampling tube | 470 | ||
| ” | 107. | Lactoscope, lactometer, and creamometer | 474 | ||
| ” | 108. | Areometric fat apparatus | 493 | ||
| ” | 109. | Babcock’s butyrometer and acid measure | 500 | ||
| ” | 110. | Gerber’s butyrometers | 502 | ||
| ” | 111. | Gerber’s centrifugal | 503 | ||
| ” | 112. | Thermometer for butyrorefractometer | 515 | ||
| ” | 113. | Apparatus for determining carbon dioxid in koumiss | 533 | ||
| ” | 114. | Cuts of mutton | 548 | ||
| ” | 115. | Cuts of beef | 548 | ||
| ” | 116. | Cuts of pork | 548 | ||
| ” | 117. | Bath for artificial digestion | 559 | ||
| ” | 118. | Bag for collecting feces | 563 | ||
| ” | 119. | Fecal bag attachment | 563 | ||
| ” | 120. | Hempel and Atwater’s calorimeter | 570 | ||
| ” | 121. | Apparatus for acetic acid | 603 | ||
| ” | 122. | Apparatus for smoking | 610 | ||
| ” | 123. | Metal distilling apparatus | 613 | ||
| ” | 124. | Distilling apparatus | 614 | ||
| ” | 125. | Improved ebullioscope | 623 | ||
VOLUME THIRD.
AGRICULTURAL PRODUCTS.
1. Introduction.—The analyst may approach the examination of agricultural products from various directions. In the first place he may desire to know their proximate and ultimate constitution irrespective of their relations to the soil or to the food of man and beast. Secondly, his study of these products may have reference solely to the determination of the more valuable plant foods which they have extracted from the soil and air. Lastly, he may approach his task from a hygienic or economic standpoint for the purposes of determining the wholesomeness or the nutritive and economic values of the products of the field, orchard, or garden. In each case the object of the investigation will have a considerable influence on the method of the examination.
It will be the purpose of the present volume to discuss fully the principles of all the standard processes of analysis and the best practice thereof, to the end that the investigator or analyst, whatever may be the design of his work, may find satisfactory directions for prosecuting it. As in the previous volumes, it should be understood that these pages are written largely for the teacher and the analyst already skilled in the principles of analytical chemistry. Much is therefore left to the individual judgment and experience of the worker, to whom it is hoped a judicious choice of approved processes may be made possible.
2. Scope Of the Work.—Under the term agricultural products is included a large number of classes of bodies of most different constitution. In general they are the products of vegetable and animal [Pg 2] metabolism. First of all come the vegetable products, fruits, grains and grasses. These may be presented in their natural state, as cereals, green fruits and fodders, or after a certain preparation, as starches, sugars and flours. They may also be met with in even more advanced stages of change, as cooked foods, alcohols and secondary organic acids, such as vinegar. In general, by the term agricultural products is meant not only the direct products of the farm, orchard and forest, but also the modified products thereof and the results of manufacture applied to the raw materials. Thus, not only the grain and straw of wheat are proper materials for agricultural analysis, but also flour and bran, bread and cakes made therefrom. In the case of maize and barley, the manufactured products may extend much further, for not only do we find starch and malt, but also alcohol and beer falling within the scope of our work. In respect of animal products, the agricultural analyst may be called on to investigate the subject of leather and tanning; to determine the composition of meat, milk and butter; to pass upon the character of lard, oleomargarine, and, in general, to determine as fully as possible the course of animal food in all its changes between the field, the packing house and the kitchen.
3. Limitations of Work.—It is evident from the preceding paragraph, that in order to keep the magnitude of this volume within the limits fixed for a single volume the text must be rigidly confined to the fundamental principles and practice of agricultural analysis. The interesting region of pharmacy and allied branches, in respect of plant analysis, can find no description here, and in those branches of technical chemistry, where the materials of elaboration are the products of the field only a superficial view can be given. The main purpose and motive of this volume must relate closely to the more purely agricultural processes.
4. General Manipulations.—There are certain analytical operations which are more or less of a general nature, that is, they are of general application without reference to the character of the material at hand. Among these may be mentioned the determination of [Pg 3] moisture and of ash, and the estimation of matters soluble in ether, alcohol and other solvents. These processes will be first described. Preliminary to these analytical steps it is of the utmost importance that the material be properly prepared for examination. In general, this is accomplished by drying the samples until they can be ground or crushed to a fine powder, the attrition being continued until all the particles are made to pass a sieve of a given fineness. The best sieve for this purpose is one having circular apertures half a millimeter in diameter. Some products, both vegetable and animal, require to be reduced to as fine a state as possible without drying. In such instances, passing the product through a sieve is obviously impracticable. Special grinding and disintegrating machines are made for these purposes and they will be described further on.
There are some agricultural products which have to be prepared for examination in special ways and these methods will be given in connection with the processes for analyzing the bodies referred to. Nearly all the bodies, however, with which the analyst will be concerned, can be prepared for examination by the general methods about to be described.
5. Preparation of the Sample. (a) Vegetable Substances.—For all processes of analysis not executed on the fresh sample, substances of a vegetable nature should, if in a fresh state, be dried as rapidly as possible to prevent fermentative changes. It is often of interest to determine the percentage of moisture in the fresh sample. For this purpose a representative portion of the sample should be rapidly reduced to as fine a condition as possible. To accomplish this it should be passed through a shredding machine, or cut by scissors or a knife into fine pieces. A few grams of the shredded material are dried in a flat-bottomed dish at progressively increasing temperatures, beginning at about 60° and ending at from 100° to 110°. The latter temperature should be continued for only a short time. The principle of this process is based upon the fact that if the temperature be raised too high at first, some of the moisture in the interior cells of the vegetable substance can be occluded by the too rapid desiccation of the exterior layers which would take place at a high temperature. The special processes for determining moisture will be given in another place. [Pg 4]
The rest of the sample should be partly dried at a lower temperature or air-dried. In the case of fodders and most cattle foods the samples come to the analyst in a naturally air-dried state. When grasses are harvested at a time near their maturity they are sun-dried in the meadows before placing in the stack or barn. Such sun-dried samples are already in a state fit for grinding. Green grasses and fodders should be dried in the sun, or in a bath at a low temperature from 50° to 60° until all danger of fermentative action is over, and then air- or sun-dried in the usual way.
Seeds and cereals usually reach the analyst in a condition suited to grinding without further preliminary preparation. Fruits and vegetables present greater difficulties. Containing larger quantities of water, and often considerable amounts of sugar, they are dried with greater difficulty. The principles which should guide all processes of drying are those already mentioned, viz., to secure a sufficient degree of desiccation to permit of fine grinding and at a temperature high enough to prevent fermentative action, and yet not sufficiently high to cause any marked changes in the constituents of the vegetable organism.
(b) Animal Substances.—The difficulties connected with the preliminary treatment of animal substances are far greater than those just mentioned. Such samples are composed of widely differing tissues, blood, bone, tendon, muscle and adipose matters, and all the complex components of the animal organism are to be considered. The whole animal may be presented for analysis, in which case the different parts composing it should be separated and weighed as exactly as possible. Where only definite parts are to be examined it is best to separate the muscle, bone, and fat as well as may be, before attempting to reduce the whole to a fine powder. The soft portions of the sample are to be ground as finely as possible in a meat or sausage cutter. The bones are crushed in some appropriate manner, and thus prepared for further examination. Where the flesh and softer portions are to be dried and finely ground, the presence of fat often renders the process almost impossible. In such cases the fat must be at least partially [Pg 5] removed by petroleum or other solvent. In practically fat-free samples the material, after grinding in a meat cutter, can be partially dried at low temperatures from 60° to 75°, and afterwards ground in much the same manner as is practiced with vegetable substances.
As is the case with the preliminary treatment of vegetable matters, it is impossible to give any general directions of universal applicability. The tact and experience of the analyst in all these cases are better than any dicta of the books. In some instances, as will appear further on, definite directions for given substances can be given, but in all cases the general principles of procedure are on the lines already indicated.
6. Preserving Samples.—In most cases, as is indicated in the foregoing paragraphs, the sample may be dried before grinding to such a degree as to prevent danger from fermentation or decay. The fine-ground samples are usually preserved in glass-stoppered bottles, carefully marked or numbered. In some cases it is advisable to sterilize the bottles after stoppering, by subjecting them to a temperature of 100° for some time. In the case of cereals assurance should be had that the samples do not contain the eggs of any of the pests that often destroy these products. As a rule, samples should be kept for a time after the completion of the analytical work, and this is especially true in all cases where there is any prospect of dispute or litigation. In general it may be said, that samples should be destroyed only when they are spoiled, or when storage room is exhausted.
7. Collecting Samples.—When possible, the analyst should be his own collector. There is often as much danger from data obtained on non-representative samples as from imperfect manipulation. When personal supervision is not possible, the sample when received, should be accompanied by an intelligible description of the method of taking it, and of what it represents. In all cases the object of the examination must be kept steadily in view. Where comparisons are to be made the methods of collecting must be rigidly the same.
The processes of analysis, as conducted with agricultural products, are tedious and difficult. The absolutely definite conditions that attend the analysis of mineral substances, are mostly lacking. The simple [Pg 6] determinations of carbon, hydrogen, nitrogen and sulfur, which are required in the usual processes of organic analysis, are simplicity itself when compared with the operations which have to be performed on agricultural products to determine their character and their value as food and raiment. We have to do here with matters on which the sustenance, health and prosperity of the human race are more intimately concerned than with any other of the sciences. This fact also emphasizes the necessity for care in collecting the materials on which the work is to be performed.
8. Grinding Samples.—In order to properly conduct the processes of agricultural analysis it is important to have the sample finely ground. This arises both from the fact that such a sample is apt to contain an average content of the various complex substances of which the material under examination is composed, and because the analytical processes can be conducted with greater success upon the finely divided matter. In mineral analysis it is customary to grind the sample to an impalpable powder in an agate mortar. With agricultural products, however, such a degree of fineness is difficult to attain, and moreover, is not necessary. There is a great difference of opinion among analysts respecting the degree of fineness desirable. In some cases we must be content with a sample which will pass a sieve with a millimeter mesh; in fact it may be found impossible, on account of the stickiness of the material, to sift it at all. In such cases a thorough trituration, so as to form a homogeneous mass will have to be accepted as sufficient. Where bodies can be reduced to a powder however, it is best to pass them through a sieve with circular perforations half a millimeter in diameter. A finer degree of subdivision than this is rarely necessary.
9. The Grinding Apparatus.—The simplest form of apparatus for reducing samples for analysis to a condition suited to passing a fine sieve is a mortar. Where only a few samples are to be prepared and in small quantities, it will not be necessary to provide anything further. After the sample is well disintegrated it is poured on the sieve and all that can pass is shaken or brushed through. The sieve is provided with a receptacle, into which it fits closely, to avoid loss of any particles which may be reduced to a dust. The top of the sieve, when [Pg 7] shaken, may also be covered if there be any tendency to loss from dust. Any residue failing to pass the sieve is returned to the mortar and the process thus repeated until all the material has been secured in the receiver. The particles more difficult of pulverization are often different in structure from the more easily pulverized portions, and the sifted matter must always be carefully mixed before the subsample is taken for examination. Often the materials, or portions thereof, will contain particles tough and resistant to the pestle, but the operator must have patience and persistence, for it is highly necessary to accurate work that the whole sample be reduced to proper size.

Figure 1. Mill for Grinding Dry Samples.
Where many samples are to be prepared, or in large quantities, mills should take the place of mortars. For properly air-dried vegetable substances, some form of mill used in grinding drugs may be employed. Grinding surfaces of chilled corrugated steel are to be preferred. The essential features of such a mill are that it be made of the best material, properly tempered, and that the parts be easily separated for convenience in cleaning. The grinding surfaces must also be so constructed and adjusted as to secure the proper degree of fineness. In [Pg 8] fig. 1 is shown a mill of rather simple construction, which has long been in satisfactory use in this laboratory. Small mills may be operated by hand power, but when they are to be used constantly steam power should be provided. In addition to the removal of nearly all the moisture by air-drying there are many oleaginous seeds which cannot be finely ground until their oil has been removed. For this purpose the grinding surfaces of the mill are opened so that the seeds are only coarsely broken in passing through. The fragments are then digested with light petroleum in a large flask, furnished with a reflux condenser. After digestion the fragments are again passed through the mill adjusted to break them into finer particles.
The alternate grinding and digestion are thus continued until the pulverization is complete. On a small specially prepared sample the total content of oil is separately determined.
Fresh animal tissues are best prepared for preliminary treatment by passing through a sausage mill. The partially homogeneous mass thus secured should be dried at a low temperature and reground as finely as possible. Where much fat is present it may be necessary to extract it as mentioned above, in the case of oleaginous seeds. In such cases both the moisture and fat in the original material should be determined on small specially prepared samples with as great accuracy as possible. Bones, hoofs, horns, hair and hides present special difficulties in preparation, which the analyst will have to overcome with such skill and ingenuity as he may possess.
The analyst will find many specially prepared animal foods already in a fairly homogeneous form, such as potted and canned meats, infant and invalid foods, and the like. Even with these substances, however, a preliminary grinding and mixing will be found of advantage before undertaking the analytical work. Many cases will arise which are apparently entirely without the classification given above. But even in such instances the analyst should not be without resources. Frequently some dry inert substance may be mixed with the material in definite quantities, whereby it is rendered more easily prepared. Perhaps no case will be presented where persistent and judicious efforts to secure a fairly homogeneous sample for analysis will be wholly unavailing. [Pg 9]

Figure 2. Comminutor for Green Samples.
In the case of green vegetable matters which require to be reduced rapidly to a fine state of subdivision in order to secure even a fairly good sample some special provision must be made. This is the case with stalks of maize and sugar cane, root crops, such as potatoes and beets, and green fodders, such as clover and grasses. The chopping of these bodies into fine fodders by hand is slow and often impracticable. The particles rapidly lose moisture and it is important to secure them promptly as in the preparation of beet pulp for polarization. For general use we have found the apparatus shown in fig. 2 quite satisfactory in this laboratory. It consists of a series of staggered circular saws carried on an axis and geared to be driven at a high velocity, in the case mentioned, 1,400 revolutions per minute. The green material is fed against the revolving saws by the toothed gear-work shown, and is thus reduced to a very fine pulp, which is received in the box below. Stalks of maize, green fodders, sugar canes, beets and other fresh vegetable matters are by this process reduced to a fine homogeneous pulp, suited for sampling and for analytical [Pg 10] operations. Such pulped material can also be spread in a fine layer and dried rapidly at a low temperature, thus avoiding danger of fermentative changes when it is desired to secure the materials in a dry condition or to preserve them for future examination. Samples of sorghum cane, thus pulped and dried, have been preserved for many years with their sugar content unchanged.

Figure 3. Rasp for Sugar Beets.
Such a machine is also useful in preparing vegetable matter for the separation of its juices in presses. Samples of sugar cane, sugar beets, apples and other bodies of like nature can thus be prepared to secure their juices for chemical examination. Such an apparatus we have found is fully as useful and indispensable in an agricultural laboratory as a drug mill for air-dried materials.
It is often desirable in the preparation of roots for sugar analysis to secure them in a completely disintegrated state, that is with the cellular tissues practically all broken. Such a pulped material can be treated with water and the sugar juices it contains thus at once distributed to all parts of the liquid mass. The operation is known as instantaneous diffusion. The pulp of the vegetable matter is thus introduced into the measuring flask along with the juices and the content of sugar can be easily determined. Several forms of apparatus have been devised for this purpose, one of which is shown in fig. 3. This process, originally devised by Pellet, has come into quite general [Pg 11] use in the determination of the sugar content of beets.[1] It is observed that it can be applied to other tubers, such as the turnip, potato, artichoke, etc. It is desirable, therefore, that an agricultural laboratory be equipped with at least three kinds of grinding machines; viz., first, the common drug mill used for grinding seeds, air-dried fodders, and the like; second, a pulping machine like the system of staggered saws above described for the purpose of reducing green vegetable matter to a fine state of subdivision, or one like the pellet rasp for tubers; third, a mill for general use such as is employed for making sausages from soft animal tissues.

Figure 4. Dreef Grinding Apparatus.
10. Grinding Apparatus at Halle Station.—The machine used at the Halle station for grinding samples for analysis is shown in Fig. 4.[2] It is so adjusted as to have both the upper and lower grinding surfaces in motion. The power is transmitted through the pulley D, which is fixed to an axis carrying also the inner grinding attachment B. Through C₂, C₃, C₄, and C₁, the reverse motion is transmitted to the outer grinder A. By means of the lever E the two grinding surfaces can be separated when the mill is to be cleaned. The dree mill above described is especially useful for grinding malt, dry brewers’ grains, cereals for starch determinations and similar dry bodies. It is not [Pg 12] suited to grinding oily seeds and moist samples. These, according to the Halle methods, are rubbed up in a mortar until of a size suited to analysis, and samples such as moist residues, wet cereals, mashes, beet cuttings, silage, etc., are dried before grinding. If it be desired to avoid the loss of acids which may have been formed during fermentation, about ten grams of magnesia should be thoroughly incorporated with each kilogram of the material before drying.
11. Preliminary Treatment of Fish.—The method used by Atwater in preparing fish for analysis is given below.[3] The same process may also be found applicable in the preparation of other animal tissues. The specimens, when received at the laboratory, are at once weighed. The flesh is then separated from the refuse and both are weighed. There is always a slight loss in the separation, due to evaporation and to slimy and fatty matters and small fragments of the tissues which adhere to the hands and the utensils employed in preparing the sample. Perfect separation of the flesh from the other parts of the fish is difficult, but the loss resulting from imperfect separation is small. The skin of the fish, although it has considerable nutritive value, should be separated with the other refuse.
The partial drying of the flesh for securing samples for analytical work is accomplished by chopping it as finely as possible and subjecting from fifty to one hundred grams of it for a day to a temperature of 96° in an atmosphere of hydrogen. After cooling and allowing to stand in the open air for twelve hours, the sample is again weighed, and then ground to a fine powder and made to pass a sieve with a half millimeter mesh. If the samples be very fat they cannot be ground to pass so fine a sieve. In such a case a coarser sieve may be used or the sample reduced to as fine and homogeneous a state as possible, and bottled without sifting.
The reason for drying in hydrogen is to prevent oxidation of the fats. As will be seen further on, however, such bodies can be quickly and accurately dried at low temperatures in a vacuum, and thus all danger of oxidation be avoided. In fact, the preliminary drying of all animal and vegetable tissues, where oxidation is to be feared, can be safely accomplished in a partial vacuum by methods to be described in another [Pg 13] place. In order to be able to calculate the data of the analysis to the original fresh state of the substance, a portion of the fresh material should have its water quantitively determined as accurately as possible.
12. Volatile Bodies.—In agricultural analysis it becomes necessary to determine the percentage of bodies present in any given sample which is volatile at any fixed temperature. The temperature reached by boiling water is the one which is usually selected. It is true that this temperature varies with the altitude and within somewhat narrow limits at the same altitude, due to variations in barometric pressure. As the air pressure to which any given body is subjected, however, is a factor in the determination of its volatile contents, it will be seen that within the altitudes at which chemical laboratories are found, the variations in volatile content will not be important. This arises from the fact that while water boils at a lower temperature, as the height above the sea level increases, the corresponding diminished air pressure permits a more ready escape of volatile matter. As a consequence, a body dried to constant weight at sea level, where the temperature of boiling water is 100°, will show the same percentage of volatile matter as if dried at an altitude where water boils at 99°. When, therefore, it is desirable to determine the volatile matter in a sample approximately at 100°, it is better to direct that it be done in a space surrounded by steam at the natural pressure rather than at exactly 100°, a temperature somewhat difficult to constantly maintain. However, where it is directed or desired to dry to constant weight exactly at 100°, it can be accomplished by means of an air-bath or by a water-jacketed-bath under pressure, or to which enough solid matter is added to raise the boiling-point to 100°. It is not often, however, that it is worth while to make any special efforts to secure a temperature of 100°. When bodies are to be dried at temperatures above 100°, such as 105°, 110°, and so on, an air-bath is the most convenient means of securing the desired end. The different kinds of apparatus to be employed will be described in succeeding paragraphs.
13. Drying at the Temperature of Boiling Water.—The best [Pg 14] apparatus for this process is so constructed as to have an interior space entirely surrounded with boiling water or steam, with the exception of the door by which entrance is gained thereto. The metal parts of the apparatus are constructed of copper, and to keep a constant level of water and avoid the danger of evaporating all the liquid, it is advisable to have a reflux condenser attached to the apparatus. It is also well to secure entrance to the interior drying oven, not only by the door, but also by small circular openings, which serve both to hold a thermometer and to permit of the aspiration of a slow stream of dry air through the apparatus during the progress of desiccation. The gaseous bodies formed by the volatilization of the water and other matters are thus carried out of the drying box and the process thereby accelerated. The bath should be heated by a burner so arranged as to distribute the flame as evenly as possible over the base. A single lamp, while it will boil the water in the center, will not keep it at the boiling-point on the sides. The temperature of the interior of the bath will not therefore reach 100°. The interior of the oven should be coated with a non-detachable carbon paint to promote the radiation of the heat from its walls, as well as to protect the parts from oxidation where acid fumes are produced during desiccation. Instead of a reflux condenser a constant water level may be maintained in the bath by means of a mariotte bottle or other similar device.

Figure 5. Water-jacketed Drying Oven.
[Pg 15] When a bath of this kind is arranged for use with a partial vacuum, it should be made cylindrical in shape, with conical ends, as shown in fig. 5, in order to bear well the pressure to which it is subjected. Among the many forms of steam-baths offered, the analyst will have but little difficulty in selecting one suited to his work. To avoid radiation the exterior of the apparatus should be covered with a non-conducting material.

Figure 6. Thermostat for Steam-Bath.
14. Drying In a Closed Water Oven.—When it is desired to keep the temperature of a drying oven exactly at 100° instead of at the heat of boiling water, a closed water oven with a thermostat is to be employed. The oven should be so constructed as to secure a free circulation of the water about the inner space. Since as a rule the water between the walls of the apparatus will be subjected to a slight pressure, these walls should be made strong, or the cylindrical form of apparatus should be used. The thermostat used by the Halle Station is shown in Fig. 6.[4] A ⋃ shaped tube, with a bulb on one arm and a lateral smaller tube sealed on the other, is partly filled with mercury and connected by rubber tubes on the right with the gas supply, and on the left with the burner. The end carrying the bulb is connected [Pg 16] directly by a rubber and metal tube with the water space of the oven. This device is provided with a valve which is left open until the temperature of the drying space reaches about 95°. The tube conducting the gas is held in the long arm of the ⋃ by means of a cork through which it passes air-tight and yet is loose enough to permit of its being moved. Its lower end is provided with a long ▲ shaped slit. When the valve leading to the water space is closed and the water reaches the boiling point, the pressure of the vapor depresses the mercury in the bulb arm of the ⋃ and raises it in the other. As the mercury rises it closes the wider opening of the ▲ shaped slit, thus diminishing the flow of gas to the burner. By moving the gas entry tube up or down a position is easily found in which the temperature of the drying space, as shown by the thermometer, is kept accurately and constantly at 100°.
In a bath arranged in this way a steam condenser is not necessary. Since, however, in laboratories which are not at a higher altitude than 1,000 feet the boiling-point of water is nearly 100°, it does not seem necessary to go to so much trouble to secure the exact temperature named. There could be no practical difference in the percentage of moisture determined at 100°, and at the boiling-point of water at a temperature not more than 1° lower.
15. Drying in an Air-Bath.—In drying a substance in a medium of hot air surrounded by steam, as has been described, the process is, in reality, one of drying in air. The apparatus usually meant by the term air-bath, however, has its drying space heated directly by a lamp, or indirectly by a stratum of hot air occupying the place of steam in the oven already described. The simplest form of the apparatus is a metal box, usually copper, heated from below by a lamp. In the jacketed forms the currents of hot air produced directly or indirectly by the lamp are conducted around the inner drying oven, thus securing a more even temperature. The bodies to be dried are held on perforated metal or asbestos shelves in appropriate dishes, and the temperature to which they are subjected is determined by a thermometer, the bulb of which is brought as near as possible to the contents of the dish. One advantage [Pg 17] of the air-bath is in being able to secure almost any desired temperature from that of the room to one of 150° or even higher. Its chief disadvantage lies in the difficulty of securing and maintaining an even temperature throughout all parts of the apparatus. Radiation from the sides of the drying oven should be prevented by a covering of asbestos or other non-combustible and non-conducting substance. The burner employed should be a broad one and give as even a distribution of the heat as possible over the bottom of the apparatus.

Figure 7. Spencer’s Drying Oven.
16. Spencer’s Air-Drying Oven.—In order to secure an even distribution of the heat in the desiccating space of the oven, Spencer has devised an apparatus, shown in the figure, in which the temperature is maintained evenly throughout the apparatus by means of a fan.[5] The oven has a double bottom, the space between the two bottoms being filled with air. The sides are also double, the space between being filled with plaster. The fan is driven by a toy engine connected with [Pg 18] the compressed air service or other convenient method. Thermometers placed in different parts of the apparatus, while in use, show a rigidly even heat at all points so long as the fan is kept in motion. The actual temperature desired can be controlled by a gas regulator. This form of apparatus is well suited to drying a large number of samples at once. Portions of liquids and viscous masses may also be dried by enclosing them in bulbs and connecting with a vacuum.
Spencer’s oven can also be used to advantage in drying viscous liquids in a partial vacuum. For this purpose the flask A, Fig. 7, containing the substance is made with a round bottom to resist the atmospheric pressure. Its capacity is conveniently from 150 to 200 cubic centimeters. It is closed with a rubber stopper carrying a trap, H Hʹ, to keep the evaporated water from falling back. The details of the construction of the trap H are shown at the right of the figure. The vapors enter at the lateral orifice, just above the bulb, while the condensed water falls back into the bulb instead of into the flask A. A series of flasks can be used at once connected through the stopcocks G with the circular tube E leading to the vacuum. A water pump easily exhausts the apparatus, maintaining a vacuum of about twenty-seven inches. The hot air in the oven is kept in motion by the fan B, thus ensuring an even temperature in every part. The flask A may be partly filled with sand or pumice stone before the addition of the samples to be dried, and the weight of water lost is determined by weighing A before and after desiccation. If it be desired to introduce a slow current of dry air or some inert gas into A, it is easily accomplished by passing a small tube, connected with the dry air or gas supply, through the rubber stopper and extending it into the flask as far as possible without coming into contact with the contents.
17. Drying Under Diminished Air Pressure.—The temperature at which any given body loses its volatile products is conditioned largely by the pressure to which it is subjected. At an air pressure of 760 millimeters of mercury, water boils at 100° but it is volatilized at all temperatures. As the pressure diminishes the temperature at which a body loses water at a given rate falls. This is a fact of importance to be considered in drying many agricultural products. This is especially [Pg 19] true of those containing oils and sugars, nearly the whole number. Invert sugar especially is apt to suffer profound changes at a temperature of 100°, the levulose it contains undergoing partial decomposition. Oils are prone to oxidation and partial decomposition at high temperatures in the presence of oxygen.
In drying in a partial vacuum therefore a double advantage is secured, that of a lower temperature of desiccation and in presence of less oxygen. It is not necessary to have a complete vacuum. There are few organic products which cannot be completely deprived of their volatile matters at a temperature of from 70° to 80° in a partial vacuum in which the air pressure has been diminished to about one-quarter of its normal force.

Figure 8. Electric Vacuum Drying Oven.
18. Electric Drying-Bath.—The heat of an electric current can be conveniently used for drying in a partial vacuum by means of the [Pg 20] simple device illustrated in Fig. 8. In ordering a heater of this kind the voltage of the current should be stated. The current in use in this laboratory has a voltage of about 120, and is installed on the three wire principle. It is well to use a rheostat with the heater in order to control the temperature within the bell jar. The ground rim of the bell jar rests on a rubber disk placed on a thick ground glass or a metal plate, making an air-tight connection. A disk of asbestos serves to separate the heater from the dish containing the sample, in order to avoid too high a temperature.
19. Steam Coil Apparatus.—For drying at the temperature of superheated steam, it is convenient to use an apparatus furnished with layers or coils of steam pipes. The drying may be accomplished either in the air or in a vacuum. In this laboratory a large drying oven, having three shelves of brass steam-tubes and sides of non-conducting material, is employed with great advantage. The series of heating pipes is so arranged as to be used one at a time or collectively. Each series is furnished with a separate steam valve, and is provided with a trap to control the escape of the condensed vapors. In the bottom of the apparatus are apertures through which air can enter, which after passing through the interior of the oven escapes through a ventilator at the top. With a pressure of forty pounds of steam to the square inch and a free circulation of air, the temperature on the first shelf of the apparatus is about 98°; on the second from 103° to 104°, and on the third about 100°. The vessels containing the bodies to be dried are not placed directly on the brass steam pipes, but the latter are first covered with thick perforated paper or asbestos. For drying large numbers of samples, or large quantities of one sample, such an apparatus is almost indispensable to an agricultural laboratory.

Figure 9. Steam Coil Drying Oven.
A smaller apparatus is shown in Fig. 9. The heating part G is made of a small brass tube arranged near the bottom in a horizontal coil and continued about the sides in a perpendicular coil. Bodies placed on the horizontal shelf are thus entirely surrounded by the heating surfaces except at the top.[6] The steam pipe S is connected with the supply by the usual method, and the escape of the condensation is controlled either by a valve or trap [Pg 21] in the usual way. The whole apparatus is covered by a bell jar B, resting on a heavy cast-iron plate P, through which also the ends of the brass coil pass. The upper surface of the iron plate may be planed, or a planed groove may be cut into it, to secure the edge of the bell jar. When the air is to be exhausted from the apparatus, a rubber [Pg 22] washer should be placed under the rim of the bell jar. The latter piece of apparatus may either be closed, as shown in the figure, by a rubber stopper, or it is better, though not shown, to have a stopper with three holes. One tube passes just through the stopper and is connected with the vacuum; the second passes to the bottom of the apparatus and serves to introduce a slow stream of dry air or of an inert gas during the desiccation. The third hole is for a thermometer. When no movement of the residual gas in the apparatus is secured, a dish containing strong sulfuric acid S’ is placed on the iron plate and under the horizontal coil, as is shown in the figure. The sulfuric acid so placed does not reach the boiling-point of water, and serves to absorb the aqueous vapors from the residual air in the bell jar. By controlling [Pg 23] the steam supply the desiccation of a sample can be secured in the apparatus at any desired temperature within the limit of the temperature of steam at the pressure used. Where no steam service is at hand a strong glass flask may be used as a boiler, in which case the trap end of the coil must be left open. The vacuum may be supplied by an air or bunsen pump. When a vacuum is not used an atmosphere of dry hydrogen may be supplied through H.

Figure 10. Carr’s Vacuum Drying Oven.

Figure 10. (Bis) Vacuum Oven Open.
20. Carr’s Vacuum Oven.—A convenient drying oven has been devised in this laboratory by Carr.[7] [Pg 24] It is made of a large tube, preferably of brass. The tube may be from six to nine inches in diameter and from twelve to fifteen inches long. One end is closed air-tight by a brass end-piece attached by a screw, or brazed. The other end is detachable and is made air-tight by ground surfaces and a soft washer. In the figure this movable end-piece is shown attached by screw-nuts, but experience has shown that these are not necessary. On the upper longitudinal surfaces are apertures for the insertion of a vacuum gauge and for attachment to a vacuum apparatus.
In the figure the thermometer and aperture for introducing dry air or an inert gas are shown in the movable end disk, but they would be more conveniently placed in the fixed end. The oven is heated below by a gas burner, which conveniently should be as long as the oven. The heat is not allowed to strike the brass cylinder directly, but the latter is protected by a piece of asbestos paper.
The temperature inside of the oven can be easily kept practically constant by means of a gas regulator, not shown in the figure, or by a little attention to the lamp. For a vacuum of twenty inches a temperature of about 80° should be maintained. When the vacuum is more complete a lower temperature can be employed. This apparatus is simple in construction, strong, cheap, and highly satisfactory in use.
21. Drying in Hydrogen.—In some of the processes of agricultural analysis it becomes important to dry the sample in hydrogen or other inert gas. This may be accomplished by introducing the dry gas desired into some form of the apparatus already described. The drying may either be accomplished in an atmosphere of hydrogen practically at rest or in a more limited quantity of the gas in motion. The latter method is to be preferred by reason of its greater rapidity. The analyst has at his command many forms of apparatus designed for the purpose mentioned above. It will be sufficient here to describe only two, devised particularly for agricultural purposes.
The first one of these, designed by the author, was intended especially for drying the samples of fodders for analysis according to the methods of the Association of Agricultural Chemists.[8]

Figure 11. Apparatus for Drying in a
Current of Hydrogen.
For the purpose of drying materials contained in flasks and tubes in a [Pg 25] current of hydrogen the apparatus shown in Fig. 11 is used. This apparatus consists of a circular box, B, conveniently made of galvanized iron, having a movable cover, S, fitted for the introduction of steam into the interior of the apparatus. Condensed steam escapes at W. A stream of perfectly pure and dry hydrogen enters at H, passes up through the material to be dried, down through the bulb V, containing sulfuric acid, and follows the direction of the arrows through the rest of the apparatus. The stream of hydrogen is thus completely dried by passing through bulbs containing sulfuric acid, on the way from one [Pg 26] piece of the apparatus to the other. A, represents a flask such as is used, with the extraction apparatus described. The apparatus which we have used will hold eight tubes or flasks at a time, and thus a single stream of hydrogen is made to do duty eight times in drying eight separate samples. The great advantage of the apparatus is in the fact that the stream of hydrogen must pass over and through the substance to be dried. In order to prevent any sulfuric acid from being carried forward into the next tube the bulb K, above the sulfuric acid, may be filled with solid pieces of soda or potash.
This apparatus has been in use for a long time and no accidents from sulfuric acid being carried forward have occurred, and there is no danger, provided the stream of hydrogen is kept running at a slow rate. If, however, by any accident the stream of hydrogen should be admitted with great rapidity, particles of the sulfuric acid might be carried forward and spoil the next sample. To avoid any such accident as this the proposal to introduce the potash bulb has been made. The apparatus works with perfect satisfaction, and it is believed that when properly adjusted check weighings can be made by weighing the bulbs, showing their increase in weight, which will give the volatile matter, and weighing the flasks or tubes, which will show the loss of weight. The only chance for error in weighing the bulbs is that some of the volatile matter may be material which is not dissolved in sulfuric acid, and is thus carried on and out of the apparatus. The blackening of the sulfuric acid in the bulbs, in the drying of all forms of organic matter, shows that the loss in weight of such bodies is not due to water alone, but also to organic volatile substances, which are capable of being decomposed by the sulfuric acid, thus blackening it.
22. Caldwell’s Hydrogen Drying-Bath.—An excellent device for drying in hydrogen has been described by Caldwell.[9] A vessel of copper or other suitable material serves to hold the tubes containing the samples to be dried. It should be about twenty-four centimeters long, fifteen high, and eight wide. This vessel is contained in another made of the same material and of the dimensions shown in the figure. On one side the edge of this [Pg 27] containing vessel may not be more than one centimeter high and the bath should rest against it. The other side is made higher to form a support for the drying tubes as indicated.

Figure 12. Caldwell’s Hydrogen Drying Apparatus.
The tube containing the substance a d is made of glass and may be closed by the ground stoppers c b or the tube stoppers e f. At a it carries a perforated platinum disk for holding the filtering felt. The tube should be about thirteen centimeters long and have an internal diameter of about twenty millimeters. With its stoppers it should weigh only a little over thirty grams. The asbestos felt should not be thick enough to prevent the free passage of gas. Passing diagonally through the bath are metal tubes, preferably made of copper, and of such a size as just to receive the glass drying tubes. If these be a little loose they should be made tight by wrapping them with a narrow coil of paper at either end of the tubular receptacle. The entrance of cold air between the glass tube and its metal holder is thus prevented, and the glass tube is held firmly in position. The glass [Pg 28] tube should be weighed with its two solid stoppers. Afterwards the sample, about two grams, is placed on the asbestos felt and the stoppers replaced and the whole reweighed. The exact weight of the sample is thus obtained. The solid stoppers are then removed and the tube stoppers inserted. The lower end of the tube is then connected with the supply of dry hydrogen. The upper tube stopper is connected by a rubber tube with a small bottle containing sulfuric acid through which the escaping hydrogen is made to bubble. A double purpose is thus secured; moisture is kept from entering the drying tube and the rate at which the hydrogen is passing is easily noted. After the drying is completed the solid stoppers are again inserted, the tube cooled in a desiccator and weighed. The loss of weight is entered as water. The tube containing the sample can afterwards be put into an extractor and treated with ether or petroleum in the manner hereafter described. This apparatus requires more hydrogen than the one previously described, but it is rather simple in construction, is easily controlled, and has given satisfactory results.

Figure 13. Liebig’s Ente.
23. Drying in Liebig’s Tubes.—In drying samples, especially of fodders, the method practiced at the Halle Station is to place them in drying tubes, the form of which is shown in Fig. 13. A stream of illuminating gas, previously dried by passing over sulfuric acid and calcium chlorid, is directed through the tubes.[10] Many of these tubes can be used at once, arranged as shown in Fig. 14. When the air is all driven out the stream of gas can be ignited so as to regulate the flow properly by the size of the flame. The tubes are held in drying ovens, as shown in the figure, the temperature of which should be kept at 105°-107°. The drying should be continued for eight or ten hours. At the end of this time the gas in the tube is to be expelled by a stream of dry air and the tubes cooled in a desiccator and weighed. There are few advantages in this method not possessed by the processes already described. The samples, moreover, are not left in a condition for further examination, either by incineration or extraction. [Pg 29]

Figure 14. Drying Apparatus used at the Halle Station.
[Pg 30] 24. Wrampelmayer’s Drying Oven.—The apparatus used at the Wageningen Station, in Holland, for drying agricultural samples, was devised by Wrampelmayer and is shown in Fig. 15. The oven is so constructed as to permit of drying in a stream of inert gas. Illuminating gas is let into the drying space of the oven through the tube A B. At B the entering gas is heated by the same lamp which boils the liquid in the water space of the apparatus. The hot gas is dried in the calcium chlorid tube c and then passes into the oven at D. At E it leaves the apparatus and is thence conducted to the lamp F, used for heating the bath. The lamp should be closed by a wire gauze diaphragm to prevent any possible explosion by reason of any admixture with the air in the oven. The condensation of the aqueous vapors is effected by means of the condenser G. In the drying space is a small shelf holder, which, by means of the hook H, can be removed from the apparatus. The drying space is closed from the upper part of the apparatus, which contains no water by the cover J, resting on a support K. This rim is covered with a rubber gasket L, by means of which the cover J can be fastened with a bayonet latch air-tight. This fastening is shown at N. Being closed in this way the part of the cylindrical oven above the cover may be left entirely open. Instead of the rather elaborate method of closing the bath, some simple and equally effective device might be used. The cover J is best made with double metallic walls enclosing an asbestos packing.

Figure 15. Wrampelmayer’s Oven.
[Pg 31] It is evident that this oven could be used with an atmosphere of carbon dioxid or of air, provided the gas for heating were derived from a separate source and the tube between E and F broken. In a drying oven designed by the author, the movable top is made with double walls and the space between is joined to the steam chamber by means of a flexible metallic tube, thus entirely surrounding the drying space with steam.
25. The Ulsch Drying Oven.—A convenient drying oven is described by Ulsch which varies from the ordinary form of a water-jacketed drying apparatus in having a series of drying tubes inserted in the water-steam space.

Figure 16. Ulsch Drying Oven.
The arrangement of the oven is shown in the accompanying figure. The water space is filled only to about one-third of its height. When the heat is applied the cock c is left open until the steam has [Pg 32] driven out all the air. It is then closed and the temperature of the bath is then regulated by the manometer e, connected with the bath by d. The bottom of the manometer cylinder contains enough mercury to always keep sealed the end of the manometer tube. The rest of the space is filled with water. At the top the manometer tube is expanded into a small bulb which serves as a gas regulator, as shown in the figure. The gas is admitted also by a small hole above the mercury in the bulb, so that when the end of the gas inlet tube is sealed enough gas still passes through to keep the lamp burning. With a mercury pressure of thirty centimeters the temperature of the bath will be about 105°. The walls of the bath should be made strong enough to bear the pressure corresponding to this degree. The drying can be accomplished either in the cubical drying box a or in the drying tubes made of thin copper and disposed as shown in the figure. The natural draft is shown by the arrows. The substance is held in boats placed in the tube as indicated. The air in traversing the tube is brought almost to the temperature of the water-steam space in which the tube lies. The natural current of hot air can easily be replaced by a stream of dry illuminating or other inert gas.
26. Drying Viscous Liquids.—In the case of cane juices, milk, and similar substances, the paper coil method may be used.[11] The manipulation is conducted as follows: A strip of filtering paper from five to eight centimeters wide and forty centimeters in length, is rolled into a loose coil and dried at the temperature of boiling water for two hours, placed in a dry glass-stoppered weighing tube, cooled in a desiccator and weighed. The stoppered weighing tube prevents the absorption of hygroscopic moisture. About three cubic centimeters of the viscous or semi-viscous liquid are placed in a flat dish covered by a plate of thin glass and weighed. The coil is then placed on end in the dish, and the greater part of the liquid is at once absorbed. The proportions between the coil and the amount of liquid should be such that the coil will not be saturated more than two-thirds of its length. It is then removed and placed dry end down in a steam-bath and dried two hours. The dish, covered by the same plate of glass, is again weighed, the loss in weight representing the quantity of liquid [Pg 33] absorbed by the coil. After drying for the time specified the coil is again placed in the hot weighing tube, cooled and its weight ascertained. The increase represents the solid matter in the sample taken. This method has been somewhat modified by Josse, who directs that it be conducted as follows:[12] Filter-paper is cut into strips from one to two centimeters wide and three meters long. The strips are crimped so they will not lie too closely together and then wrapped into coils. These coils can absorb about ten cubic centimeters of liquid. One of them is placed in a flat dish about two centimeters high and seven in diameter, and dried as described, covered, cooled and weighed. There are next placed in the dish and weighed one or two grams of the massecuite, molasses, etc., which are to be dried and the dish again weighed and the total weight of the matter added, determined by deducting the weight of the dish and cover. About eight cubic centimeters of water are added, the material dissolved with gentle warming, the coil placed in the dish, and the whole dried for two hours. The cover is then replaced and the whole cooled in a desiccator and weighed. The increase in weight represents the dry matter in the sample taken.
The above method of solution of a viscous sample in order to divide it evenly for desiccation is based on the principle of the method first proposed by the author and Broadbent for drying honeys and other viscous liquids.[13] In this process the sample of honey, molasses, or other viscous liquid is weighed in a flat dish, dissolved in eighty per cent alcohol, and then a weighed quantity of pure dry sand added, sufficient to fill the dish three-quarters full. The alcoholic solution of the viscous liquid is evenly distributed throughout the mass of sand by capillary attraction, and thus easily and rapidly dried when placed on the bath.
Pumice stone, on account of its great porosity, is also an excellent medium for the distribution of a viscous liquid in aiding the process of desiccation. The method has been worked out in great detail in this laboratory by Carr and Sanborn,[14] and most excellent results obtained. Round aluminum dishes two centimeters high and from eight to ten centimeters in diameter are conveniently used for this process. The pumice stone is dried and broken into fragments the size of a pea before use. [Pg 34]
27. General Principles of Drying Samples.—It would be a needless waste of space to go into further details of devices for desiccation. A sufficient number has been given to fully illustrate all the principles involved. In general, it may be said that drying in the open air at a temperature not exceeding that of boiling water can be safely practiced with the majority of samples. For instance, we have found practically no change in this laboratory in the composition of cereals dried in the air and in an inert gas. The desiccation should in all cases be accomplished as speedily as possible. To this end the atmosphere in contact with the sample should be dry and kept in motion. An oven surrounded by boiling water and steam is to be preferred to one heated by air. Constancy of temperature is quite as important as its degree and this steadiness is most easily secured by steam at atmospheric pressure. Where higher temperatures than 100° are desired the steam must be under pressure, or the boiling-point of the water may be raised by adding salt or other soluble matters. A bath of paraffin or calcium chlorid may also be used or a sand or air-bath may be employed. The analyst must not forget, however, that inorganic matters are prone to change at temperatures above 100°, even in an inert atmosphere, and higher temperatures must be used with extreme caution.
Drying in partial vacuum and in a slowly changing atmosphere may be practiced with all bodies and must be employed with some. The simple form of apparatus already described will be found useful for this purpose. At a vacuum of twenty inches or more, even unstable organic agricultural products are in little danger of oxidation. In the introduction of a dry gas, therefore, air will be found as a rule entirely satisfactory. In the smaller form of vacuum apparatus described, however, there is no objection to the employment of hydrogen or of carbon dioxid. The gas entering the apparatus should be dried by passing over calcium chlorid or by bubbling through sulfuric acid. In this laboratory the vacuum is provided by an air-pump connected with a large exhaust cylinder. This cylinder is connected by a system of pipes to all the working desks. The chief objection to this system is the [Pg 35] unsteadiness of the pressure. When only a few are using the vacuum apparatus for filtering or other purposes the vacuum will stand at about twenty inches. When no one is using it the vacuum will rise to twenty-eight or twenty-nine inches. At other times, when in general use, it may fall to fifteen inches. Where a constant vacuum is desired for drying, therefore, it is advisable to connect the apparatus with a special aspirator which will give a pressure practically constant.
The dishes containing the sample should be low and flat, exposing as large a surface as possible. For viscous liquids it will be found advisable to previously fill the dishes with pumice stone or other inert absorbent material to increase the surface exposed.
The special methods of drying milk, sirup, honeys, and like bodies, will be described in the paragraphs devoted to these substances.
In drying agricultural products, not only water but all other matters volatile at the temperature employed are expelled. It is only necessary to conduct the products of volatilization through sulfuric acid to demonstrate the fact that organic bodies are given off. In the case mentioned the sulfuric acid will be speedily changed to a brown and even black color by these bodies. It is incontestable, however, that in most cases the essential oils and other volatile matters thus escaping are not large in quantity and could not appreciably affect the percentage composition of the sample. In such cases the whole of the loss on drying is entered in the note book as water. There are evidently many products, however, where a considerable percentage of the volatile products is not water. The percentage of essential oils, which have a lower boiling-point than water, can be determined in a separate sample and this deducted from the total loss on drying will give the water.
Simple as it seems, the determination of water in agricultural products often presents peculiar difficulties and taxes to the utmost the patience and skill of the analyst. Having set forth the substantial principles of the process and indicated its more important methods, there is left for the worker in the laboratory the choice of processes [Pg 36] already described, or, in special cases, the device of new ones and adaption of old ones to meet the requirements of necessity.
28. Determination of Ash.—The principle to be kept in view in the preparation of the ash of agricultural products is to conduct the incineration at as low a temperature as possible to secure a complete combustion. The danger of too high a temperature is two-fold. In the first place some of the mineral constituents constantly present in the ash, notably, some of the salts of potassium and sodium are volatile at high temperatures and thus escape detection. In the second place, some parts of the ash are rather easily fusible and in the melted state occlude particles of unburned organic matter, and thus protect them from complete oxidation. Both of these dangers are avoided, and an ash practically free of carbon obtained, by conducting the combustion at the lowest possible temperature capable of securing the oxidation of the carbonaceous matter.
29. Products Of Combustion.—The most important product of combustion, from the present point of view, is the mineral residue obtained. The organic matter of the sample undergoes decomposition in various ways, depending chiefly on its nature. Complex volatile compounds are formed first largely of an acid nature. The residual carbon is oxidized to carbon dioxid and the hydrogen to water. The relative proportions of these bodies formed, in any given case, depend on the conditions of combustion. With a low temperature and a slow supply of oxygen, the proportion of volatile organic compounds is increased. At a high temperature, and in a surplus of oxygen, the proportions of water and carbon dioxid are greater. At the present time, however, our attention is to be directed exclusively to the mineral residue; the organic products of combustion belonging to the domain of organic chemistry. As has already been intimated, the ash of agricultural samples consists of the mineral matters derived from the tissues, together with any accidental mineral impurities which may be present, some unburned carbon, and the sulfur, phosphorus, chlorin, nitrogen, etc., existing previously in combination with the mineral bases. The organic sulfur and phosphorus may also undergo complete or [Pg 37] partial oxidation during incineration and be found in the ash. Unless special precautions be taken, however, a portion of the organic sulfur and phosphorus may escape as volatile compounds during the combustion.[15] The organic nitrogen is probably completely lost, at most, only traces of it being oxidized during the combustion in such a way as to combine with a mineral base. The rare mineral elements that are taken up by plants will also be found in the ash. Here the analyst would look for copper, boron, zinc, manganese, and the other elements which, when existing in the soil, are apt to be found in the tissues of the plants, not, perhaps, as organic or essential compounds, but as concomitants of the other mineral foods absorbed by growing vegetation. This fact is often of importance in toxicological and hygienic examinations of foods. For instance, traces of copper or of boron in the ash of a prescribed food would not be evidence of the use of copper or borax salts as preservatives unless it could be shown that the soil on which the food in question was grown was free of these bodies.
This fact manifestly applies only to those cases where mere traces of these rare bodies are in question. The presence of considerable quantities of them, enough to be inimical to health, could only be attributed to artificial means.
30. Purpose and Conduct of Incineration.—In burning a sample of an agricultural product the analyst may desire to secure either a large sample of ash for analytical purposes as already described or to determine the actual percentage of ash. The first purpose is secured in many ways. In the preparation of ash for manurial purposes, for instance, little care is exercised either to prevent volatilization of mineral matters or to avoid the occurrence of a considerable quantity of carbon in the sample. With this operation we have, at present, nothing whatever to do. In preparing a sample of ash for chemical analysis it is important, where a sufficient quantity of the sample can be obtained, to use as large a quantity of it as convenient. While it is true that very good results may be secured on very small samples, it is always advisable to have a good supply of the material at hand. Since the materials burned have only from one to three per cent of ash, a kilogram of them will supply only from ten to thirty grams. To supply [Pg 38] all needful quantities of material and replace the losses due to accident, whenever possible at least twenty grams of the ash should be prepared. The combustion can be carried on in platinum dishes with all bodies free of metallic oxids capable of injuring the platinum. Otherwise porcelain or clay dishes may be employed. As a rule the combustion is best conducted in a muffle at a low red heat. With substances very rich in fusible ash, as for instance the cereals, it is advisable to first char them, extract the greater part of the ash with water, and afterwards burn the residual carbon. The aqueous extract can then be added to the residue of combustion and evaporated to dryness at the temperature of boiling water. During the combustion the contents of the dish should not be disturbed until the carbon is as completely burned out as possible. The naturally porous condition in which the mass is left during the burning is best suited to the entire oxidation of the carbon. At the end however, it may become necessary to bring the superficial particles of unburned carbon into direct contact with the bottom of the dish by stirring its contents. In most instances very good results may be obtained by burning the ash in an open dish without the aid of a muffle. In this case a lamp should be used with diffuse flame covering as evenly as possible the bottom of the dish and thus securing a uniform temperature. The carbon, when once in active combustion, will as a rule be consumed, and an ash reasonably pure be obtained.
The second purpose held in view by the analyst is to determine the actual content of ash in a sample. For this purpose only a small quantity of the material should be used, generally from two to ten grams. The combustion should be conducted in flat-bottomed, shallow dishes, and at a low temperature. In many cases the residue, after determining the moisture, can be at once subjected to incineration, and thus an important saving of time be secured. A muffle, with gentle draft, will be found most useful for securing a white ash. The term, white ash, is sometimes a deceptive one. In samples containing iron or manganese, the ash may be practically free of carbon and yet be highly colored. The point at which the combustion is to be considered as [Pg 39] finished therefore should be at the time the carbon has disappeared rather than when no coloration exists. In general the methods of incineration are the same for all substances, but some cases may arise in which special processes must be employed. Some analysts prefer to saturate the substance before incineration with sulfuric acid, securing thus a sulfated ash. This is practiced especially with molasses. In such cases the ash obtained is free of carbon dioxid and roughly the difference in weight is compensated for by deducting one-tenth of the weight of the ash when comparison is to be made with ordinary carbonated ash. Naturally this process could not be used when sulfuric acid is to be determined in the product.

Figure 17. Courtoune Muffle.
31. German Ash Method.—The method pursued at the Halle Station for securing the percentage of ash in a sample is as follows:[16] Five grams of the air-dried sample are incinerated in a platinum dish and the ash ignited until it has assumed a white, or at least a bright gray tint. As soon as combustible gases are emitted at the beginning of the incineration they are ignited and allowed to burn as long as possible. It is advisable to hasten the oxidation by stirring the mass with a piece of platinum wire. If the ash should become agglomerated, as sometimes happens with rich food materials, it must be separated by attrition. The ash, when cooled on a desiccator, is to be weighed. When great exactness is required, it is advised, as set forth in a former [Pg 40] paragraph, to first carbonize the mass and then extract the soluble ash with hot water before completing the oxidation. When the latter is complete and the dish cooled the aqueous extract is added, evaporated to dryness and the incineration completed.
32. Courtonne’s Muffle.—The ordinary arrangement of a muffle, as in assaying, may be conveniently used in incineration. A special muffle arrangement has been prepared by Courtonne which not only permits of the burning of a large number of samples at once, but also effects a considerable saving in gas. The muffle as shown in Fig. 17, is made in two stages, and the floor projects in front of the furnace, forming a convenient hearth. The incineration is commenced on the upper stage, where the temperature is low, and finished on the lower one at a higher heat. The furnace is so arranged as to permit the flame of the burning gas to entirely surround the muffle. The draft and temperature within the muffle are controlled by the fire-clay door shown resting on the table.
33. Object Of Treatment.—The next step, in the analytical work, after sampling, drying, and incinerating, is the treatment of the sample with solvents. The object of this work is to separate the material under examination into distinct classes of bodies distinguished from each other by their solubilities. It is not the purpose of this section to describe the various bodies which may be separated in this way, especially from vegetable products. For this description the reader may consult the standard works on plant analysis.[17]
The chief object of a strictly agricultural examination of a field or garden product is to determine its food value. This purpose can be accomplished without entering into a minute separation of nearly allied bodies. For example, in the case of carbohydrates it will be sufficient as a rule, to separate them into four classes. In the first class will be found those soluble in water as the ordinary sugars. In the second group will be found those which, while not easily soluble in water, are readily rendered so by treatment with certain ferments or by hydrolysis with an acid. The starches are types of this class. In the third place [Pg 41] are found those bodies which resist the usual processes of hydrolysis either with an acid or alkali, and therefore remain in the residue as fiber. Cellulose is a type of these bodies. In the fourth class are included those bodies which on hydrolysis with an acid yield furfurol on distillation, and therefore belong to the type containing five atoms of carbon or some multiple thereof in their molecule. For ordinary agricultural purpose the separation is not even as complete as is represented above.
What is true of the carbohydrates applies equally well to the fats and to other groups. Especially in the analysis of cereals and of cattle foods, the treatment with solvents is confined to the use in successive order of ether or petroleum, alcohol, dilute acids, and alkalies, the latter at a boiling temperature. The general method of treatment with these solvents will be the subject of the following paragraphs.
34. Extraction of the Fats and Oils.—Two solvents are in general use for the extraction of fats and oils; viz., ethylic ether and a light petroleum. The former is the more common reagent. Before use it should be made as pure as possible by washing first with water, afterwards removing the water by lime or calcium chlorid, and then completing the drying by treatment with metallic sodium. The petroleum spirit used should be purified by several fractional distillations until it has nearly a constant boiling-point of from 45° to 50°. The detailed methods of preparing these reagents will be given in another place. For rigid scientific determinations the petroleum is to be preferred to the ether. It is equally as good a solvent for fats and oils and is almost inert in respect to other vegetable constituents. Ether, on the other hand, dissolves chlorophyll and its partial oxidation products, resins, alkaloids and the like. The extract obtained by ether is therefore less likely to be a pure fat than that secured by petroleum. For purposes of comparison, however, the ether should be employed, inasmuch as it has been used almost exclusively in analytical operations in the past.
35. Methods Of Extraction.—The simplest method for accomplishing the extraction of fat from a sample consists in treating [Pg 42] it with successive portions of the solvent in an open dish or a closed flask. This process is actually employed in some analytical operations, as, for instance, in the determination of fat in milk. Experience has shown, however, that a portion of the substance soluble, for instance, in ether, passes very slowly into solution, so that a treatment such as that just described would have to be long continued to secure maximum results. The quantity of solvent required would thus become very large and in the case of ether would entail a great expense. For the greater number of analytical operations, therefore, some device is employed for using the same solvent continually. The methods of extraction therefore fall into two general classes; viz., extraction by digestion and extraction by percolation. This classification holds good also for other solvents besides ether and petroleum. In general, the principles and practice of extraction described for ether may serve equally well for alcohol, acetone and other common solvents.
36. Extraction by Digestion.—In the use of ether or petroleum the sample is covered with an excess of the solvent and allowed to remain for some time in contact therewith. The soluble portions of the sample diffuse into the reagent. The speed of diffusion is promoted by stirring the mixtures. The operation may be conducted in an open dish or a flask. Inasmuch as the residue is, as a rule, to be dried and weighed, an open dish is to be preferred. To avoid loss of reagent and to prevent filling a working room with very dangerous gases, the temperature of digestion should be kept below the boiling-point of the solvent. The greater part of the soluble matter will be extracted with three or four successive applications of the reagent, but, as intimated above, the last portions of the soluble material are extracted with difficulty by this process. In pouring off the solvent care must be exercised to avoid loss of particles of the sample suspended therein. To this end it is best to pour the solvent through a filter. For the extraction of large quantities of material for the purpose of securing the extract for future examination, or simply to remove it, the digestion process is usually employed. This excess of solvent required is easily recovered by subsequent distillation and used again. The method is rarely used for the quantitive estimation of the extract, the [Pg 43] process of continuous percolation being more convenient and more exact.
37. Extraction by Percolation.—In this method the solvent employed is poured on the top of the material to be extracted and allowed to pass through it usually by gravitation alone, sometimes with the help of a filter-pump. The principle of the process is essentially that of washing precipitates.
Two distinct forms of apparatus are in use for this process. In the first kind the solvent is poured over the material and after percolation is secured by distillation in another apparatus. In the second kind the solvent is secured after percolation in a flask where it is at once subjected to distillation. The vapors of the solvent are conducted by appropriate means to a condenser placed above the sample. After condensation the solvent is returned to the upper part of the sample. The percolation thus becomes continuous and a very small quantity of the solvent may thus be made to extract a comparatively large amount of material. This process is particularly applicable to the quantitive determination of the extract. After distillation and drying the latter may be weighed in the flask in which it was received or the sample may be dried and weighed in the vessel in which it is held both before and after extraction. One great advantage of the continuous extraction method lies in the fact that when it is once properly started it goes on without further attention from the analyst save an occasional examination of the flow of water through the condenser and of the rate of the distillation. For this reason the process may be continued for many hours without any notable loss of time. The vapor of the solvent in passing to the condenser may pass through a tube out of contact with the material to be extracted or it may pass directly around the tube holding the sample. In the former case the advantage is secured of conducting the extraction at a higher temperature, but there is danger of boiling the solvent in contact with the material and thus permitting the loss of a portion of the sample.
38. Apparatus Used for Extractions.—For extraction by digestion, as has already been said, an open dish may be used. When large quantities of material are under treatment, heavy flasks, holding [Pg 44] from five to ten liters, will be found convenient. In these cases a condenser can be attached to the flask and the extraction conducted at the boiling temperature of the solvent. During the process of extraction it is advisable to shake the flask frequently. By proceeding in this way the greater part of the solvent matter will be removed after three or four successive treatments.
In extraction by percolation various forms of apparatus are employed. The ordinary percolators of the manufacturing pharmacist may be used for the larger operations, while the more elaborate forms of continuous extractors will be found most convenient for quantitive work. In each case the analyst must choose that process and form of apparatus best suited to the purpose in view. In the next paragraphs will be described some of the more common forms of apparatus in use.
39. Knorr’s Extraction Apparatus.—The apparatus which has been chiefly used in this laboratory for the past few years is shown in the accompanying figure.[18] The principle of the construction of the apparatus lies in the complete suppression of stoppers and in sealing the only joint of the device with mercury.
The construction and operation of the apparatus will be understood by a brief description of its parts.
A is the flask containing the solvent, W a steam bath made by cutting off the top of a bottle, inverting it and conducting the steam into one of the tubes shown in the stopper while the condensed water runs out of the other. The top of the bath is covered with a number of concentric copper rings, so that the opening may be made of any desirable size. B represents the condenser, which is a long glass tube on which a number of bulbs has been blown, and which is attached to the hood for holding the material to be extracted, as represented at Bʹ, making a solid glass union. Before joining the tube at Bʹ the rubber stopper which is to hold it into the outside condenser of B is slipped on, or the rubber stopper may be cut into its center and slipped over the tube after the union is made. In case alcohol is to be used for the solvent, requiring a higher temperature, the flask holding the solvent is placed entirely within the steam-bath, as represented at Aʹ. [Pg 45]

Figure 18. Knorr’s Extraction Apparatus.

Figure 19. Extraction Flask.

Figure 20.
Extraction Tube.

Figure 21.
Extraction Siphon Tube.
A more detailed description of the different parts of the apparatus can be seen by consulting Figs. 19, 20, and 21. In A, Fig. 19, is represented a section of the flask which holds the solvent, showing how the sides of the hood containing the matters to be extracted pass over [Pg 47] the neck of the flask, and showing at S a small siphon inserted in the space between the neck of the flask and the walls of the hood for the purpose of removing any solvent that may accumulate in this space. A view of the flask itself is shown at Aʹ. It is made by taking an ordinary flask, softening it about the neck and pressing the neck in so as to form a cup, as indicated at Aʹ, to hold the mercury which seals the union of the flask with the condenser. The flask is held in position by passing a rubber band below it, which is attached to two glass nipples, b, blown onto the containing vessel, as shown in Fig. 18. The material to be extracted may be contained in an ordinary tube, as shown in Fig. 20, which may be made from a test tube drawn out, as indicated in the figure, having a perforated platinum disk sealed in at D. The containing tube rests upon the edges of the flask containing the solvent by means of nipples shown at t. If a siphon tube is to be used, one of the most convenient forms is shown in Fig. 21, in which the siphon lies entirely within the extracting tube, thus being protected from breakage. By means of this apparatus the extractions can be carried on with a very small quantity of solvent, there being scarcely any leakage, even with the most volatile solvents, such as ether and petroleum. The apparatus is always ready for use, no corks are to be extracted, and no ground glass joints to be fitted.
40. Soxhlet’s Extraction Apparatus.—A form of continuous extraction apparatus has been proposed by Soxhlet which permits the passage of the vapors of the solvent into the condenser by a separate tube and the return of the condensed solvent after having stood in contact with the sample, to the evaporating flask by a siphon. The advantage of this process lies in freeing the sample entirely from the rise of temperature due to contact with the vapors of the solvent, and in the second place in the complete saturation of the sample with the solvent before siphoning. The sample is conveniently held in a cylinder of extracted filter-paper open above and closed below. This is placed in the large tube between the evaporating flask and the condenser. The sample should not fill the paper holder, and if disposed to float in the solvent, should be held down with a plug of asbestos fiber or of glass wool. The extract may be transferred, by dissolving in the [Pg 48] solvent, from the flask to a drying dish, or it may be dried and weighed in the flask where first received.

Figure 22.
Soxhlet
Extraction
Apparatus.
There are many forms of apparatus of this kind, one of which is shown in Fig. 22, but a more extended description of them is not necessary. The disadvantages of this process as compared with Knorr’s, are quite apparent. The connections with the evaporating flask and condenser are made with cork stoppers, which must be previously thoroughly extracted with ether and alcohol. These corks soon become dry and hard and difficult to use. The joints are likely to leak, and grave dangers of explosion arise from the vapors of the solvents escaping into the working room. Moreover, it is an advantage to have the sample warmed by the vapors of the solvent during the progress of the extraction, provided the liquid in direct contact with the sample does not boil with sufficient vigor to cause loss.
The use of extraction apparatus with ground glass joints is also unsatisfactory. By reason of unequal expansion and contraction these joints often are not tight. They are also liable to break and thus bring danger and loss of time.
41. Compact Extraction Apparatus.—In order to bring the extraction apparatus into a more compact form, the following described device has been successfully used in this laboratory.[19] The condenser employed is made of metal and is found entirely within the tube holding the solvent.
This form of condenser is shown in Fig. 23, in which the tube E serves to introduce the cold water to the bottom of the condensing device. The tube D serves to carry away the waste water. The tube F serves for the introduction of the solvent by means of a small funnel. When the solvent is introduced and has boiled for a short time, the tube F should be closed. In each of the double conical sections of the condenser a circular disk B is found, which causes the water flowing from A upward to pass against the metallic surfaces of the condenser. [Pg 49]
A section of the double conical condenser is shown in the upper right hand corner. It is provided with two small hooks hh, soldered on the lower surface, by means of which the crucible G can be hung with a platinum wire. The condenser is best made smooth and circular in form.
The crucible G, which holds the material to be extracted, can be made of platinum, but for sake of economy also of porcelain. The bottom of the porcelain crucible is left open excepting a small shelf, as indicated, which supports a perforated disk of platinum on which an asbestos film is placed.

Figure 23. Compact Condensing Apparatus.
The whole apparatus is of such size as to be easily contained in the large test-tube T.
[Pg 50] The mouth of the test-tube is ground so as to fit as smoothly as possible to the ground-brass plate of the metallic condenser P.
In case it is desired to weigh the extract it may be done directly by weighing it in the test-tube T after drying in the usual way at the end of the extraction; or a glass flask H, made to fit freely into the test-tube, may be used, in which case a little mercury is poured into the bottom of the tube to seal the space between H and T. To prevent spirting of the substance in H, or projecting any of the extracted material without or against the bottom of the crucible G, the funnel represented by the dotted lines in the right hand section may be used.
Heat may be applied to the test-tube either by hot water, or steam, or by a bunsen, which permits of the flame being turned down to minimum proportions without danger of burning back. When the test-tube alone is used it is advisable to first put into it some fragments of pumice stone, particles of platinum foil, or a spoonful of shot, to prevent bumping of the liquid when the lamp is used as the source of heat.
Any air which the apparatus contains is pushed out through F when the boiling begins, the tube F not being closed until the vapor of the liquid has reached its maximum height. With cold water in the condenser the vapor of ether very rarely reaches above the lower compartment and the vapor of alcohol rarely above the second.
When the plate P is accurately turned so as to fit the ground surface of the mouth of T, it is found that ten cubic centimeters of anhydrous ether or alcohol are sufficient to make a complete extraction, and there is not much loss of solvent in six hours. The thickness of the asbestos film in G, or its fineness, is so adjusted as to prevent too rapid filtration so that the solvent may just cover the material to be extracted, or, after the material is placed in a crucible, a plug of extracted glass wool may be placed above it for the purpose of distributing the solvent evenly over the surface of the material to be extracted and of preventing the escape of fine particles. [Pg 51]

Figure 24. Improved Compact Extraction Apparatus.
In very warm weather the apparatus may be arranged as shown in figure 24. The bath for holding the extraction tubes is made in two parts, K and Kʹ. The bath K has a false bottom shown in the dotted line O, perforated to receive the ends of the extraction tubes and which holds them in place and prevents them from touching the true bottom, where they might be unequally heated by the lamp. The upper bath Kʹ has a [Pg 52] perforated bottom, partly closed with rubber-cloth diaphragms Gʹ Nʹ Hʹ. The extraction tubes passing through this bath, water-tight, permit broken ice or ice-water to be held about their tops, and thus secure a complete condensation of the vapors of the solvent which in warm weather might escape the metal condenser. In practice care must be taken to avoid enveloping too much of the upper part of the extraction tube with the ice-water, otherwise the vapors of the solvent will be chiefly condensed on the sides of the extraction tube and will not be returned through the sample. It is not often that the upper bath is needed, and then only with ether, never with alcohol. This apparatus has proved especially useful with alcohol, using, as suggested, glycerol in the bath. The details of its further construction and arrangement are shown in the figure. The extraction tubes are most conveniently arranged in a battery of four, one current of cold water passing in at A and out at B, serving for all. The bath is supported on legs long enough to allow the lamp plenty of room. The details of the condenser M are shown in Bʹ, Aʹ, T, Fʹ, and Lʹ. Instead of a gooch Lʹ for holding the sample a glass tube R, with a perforated platinum disk Q, may be used. The water line in the bath is shown by W. This apparatus may be made very cheaply and without greatly impairing its efficiency by using a plain concentric condenser and leaving off the upper bath Kʹ.
42. Solvents Employed.—It has already been intimated that the chief solvents employed in the extraction of agricultural samples are ether or petroleum and aqueous alcohol. The ether used should be free of alcohol and water, the petroleum should be subjected to fractional distillation to free it of the parts of very high and very low boiling points, and the alcohol as a rule should contain about twenty per cent of water.
There are many instances, however, where other solvents should be used. The use of aqueous alcohol is sometimes preceded by that of alcohol of greater strength or practically free of water. For the extraction of soluble carbohydrates (sugars) cold or tepid water is employed, the temperature of which is not allowed to rise high enough to act upon starch granules. For the solution of the starch itself an acid solvent [Pg 53] is used at a boiling temperature, whereby the starch molecules undergo hydrolysis and form dextrin or soluble sugars (maltose, dextrose). By this process also the carbohydrates, whose molecules contain five, or some multiple thereof, atoms of carbon form soluble sugars of which xylose and arabinose are types. The solvent action of acids followed by treatment with dilute alkalies at a boiling temperature, completes practically the solution of all the carbohydrate bodies, save cellulose and nearly related compounds. The starch carbohydrates are further dissolved by the action of certain ferments such as diastase.
Dilute solutions of mineral salts exert a specific solvent action on certain nitrogenous compounds and serve to help separate the albuminoid bodies into definite groups.
Under the proper headings the uses of these principal solvents will be described, but a complete discussion of their action, especially on samples of a vegetable origin, should be looked for in works on plant analysis.[20]
The application of acids and alkalies for the extraction of carbohydrates, insoluble in water and alcohol, will be described, in the paragraphs devoted to the analysis of fodders and cereals. The extraction of these matters, made soluble by ferments, will be discussed in the pages devoted to starch and artificial digestion. It is thus seen that the general preliminary treatment of a sample preparatory to specific methods of examination is confined to drying, extraction with ether and alcohol, and incineration.
43. Recovery of the Solvent.—In using such solvents as ether, chloroform, and others of high value, it is desirable often to recover the solvent. Various forms of apparatus are employed for this purpose, arranged in such a way as both to secure the solvent and to leave the residue in an accessible condition, or in a form suited to weighing in quantitive work. When the extractions are made according to the improved method of Knorr, the flask containing the extract may be at once connected with the apparatus shown in figure 25.[21] A represents the flask containing the solvent to be recovered, W the steam-bath, B the condenser sealed by mercury, M and R the flask receiving the products of condensation. It will be found economical to save ether, alcohol, and chloroform even when only a few cubic centimeters remain after the extraction is complete. In the figure the neck of the flask A is represented as narrower than it really is. The open end of the connecting tube, which is sealed on A by mercury, should be the same size as the tube connecting with the condenser in the extraction apparatus. [Pg 54]

Figure 25.—Knorr’s Apparatus for
Receiving Solvents.

Figure 26. Apparatus for Recovering Solvents
from Open Dishes.
It often happens that materials which are dissolved by the ordinary [Pg 56] solvents in use are to be collected in open dishes in order that their properties may be studied. At the same time large quantities of solvents must be used, and it is desirable to have some method of recovering them. The device shown in Fig. 26 has been found to work excellently well for this purpose.[22] It consists of a steam-bath, W, and a bottle, B, with the bottom cut off, resting on an iron dish, P, containing a small quantity of mercury, enough to seal the bottom of the bottle. The dish containing the solvent is placed on the mercury, and the bottle placed down over it, forming a tight joint. On the application of steam the solvent escapes into the condenser, C, and is collected as a liquid in the flask A. In very volatile solvents the flask A may be surrounded with ice, or ice-cold water passed through the condenser. When an additional quantity of the solvent is to be added to the dish for the purpose of evaporating it is poured into the funnel F, and the stopcock H opened, which allows the material to run into the dish in B without removing the bottle. In this way many liters of the solvent may be evaporated in any one dish, and the total amount of extract obtained together. At the last the bottle B is removed, and the extract which is found in the dish is ready for further operations.
[1] Sidersky: Traité d’Analyse des Matières Sucrées, p. 311.
[2] Die Agricultur-Chemische Versuchs-Station, Halle a/S., S. 34. (Read Dreef instead of Dree.)
[3] Report of Commissioner of Fish and Fisheries, 1888, p.686.
[4] Vid. op. cit. 2, p. 14.
[5] Journal of the American Chemical Society, Vol. 15, p. 83.
[6] Chemical Division, U. S. Department of Agriculture, Bulletin No. 28, p. 101.
[7] Not yet described in any publication. Presented at 12th annual meeting of the Association of Agricultural Chemists, Aug. 7th, 1895.
[8] Vid. op. cit. 6, p. 100.
[9] Cornell University Agricultural Experiment Station, Bulletin 12.
[10] (bis. p. 28). Vid. op. cit. 2, p. 15.
[11] Bulletin No. 13, Chemical Division, U. S. Department of Agriculture, Part First pp. 85-6.
[12] Bulletin de 1’ Association des Chimistes de Sucrerie, 1893, p. 656.
[13] Chemical News, Vol. 52, p. 280.
[14] Presented to 12th Annual Convention of the Association of Official Agricultural Chemists, Sept. 7th, 1895.
[15] Vid. Volume First, p. 411.
[16] Vid. op. cit. 2, p. 17.
[17] Dragendorff, Plant Analysis.
[18] Vid. op. cit. 6, p. 96.
[19] Journal of Analytical and Applied Chemistry, Vol. 7, p. 65, and Journal of the American Chemical Society, March 1893.
[20] Vid. op. cit. 16.
[21] Vid. op. cit. 6, p. 99.
[22] Vid. op. cit. 6, p. 103.
44. Introduction.—Carbohydrates, of which sugars and starches are the chief representatives, form the great mass of the results of vegetable metabolism. The first functions of the chlorophyll cells of the young plant are the condensation of carbon dioxid and water. The simplest form of the condensation is formaldehyd, CH₂O. There is no convincing evidence, however, that this is the product resulting from the functional activity of the chlorophyll cells. The first evidence of the condensation is found in more complex molecules; viz., those having six atoms of carbon. It is not the purpose of this work to discuss the physiology of this process, but the interested student can easily find access to the literature of the subject.[23] When a sample of a vegetable nature reaches the analyst he finds by far the largest part of its substance composed of these products of condensation of the carbon dioxid and water. The sugars, starches, pentosans, lignoses, and celluloses all have this common origin. Of many air-dried plants these bodies form more than eighty per cent.
In green plants the sugars exist chiefly in the sap. In plants cut green and quickly dried by artificial means the sugars are found in a solid state. They also exist in the solid state naturally in certain sacchariferous seeds. Many sugar-bearing plants when allowed to dry spontaneously lose all or the greater part of their sugar by fermentation. This is true of sugar cane, sorghum, maize stalks, and the like. The starches are found deposited chiefly in tubers, roots or seeds. In the potato the starch is in the tuber, in cassava the tuber holding the starch is also a root, in maize, rice and other cereals the starch is in the seeds. The wood-fibers; viz., pentosans, lignose, cellulose, etc., form the framework and support of the plant structure. Of all these carbohydrate bodies the most important as foods [Pg 59] are the sugars and starches, but a certain degree of digestibility cannot be denied to other carbohydrate bodies with the possible exception of pure cellulose. In the following paragraphs the general principles of determining the sugars and starches will be given and afterwards the special processes of extracting these bodies from vegetable substances preparatory to quantitive determination.
45. Nomenclature.—In speaking of sugars it has been thought best to retain for the present the old nomenclature in order to avoid confusion. The terms dextrose, levulose, sucrose, etc., will therefore be given their commonly accepted significations.
A more scientific nomenclature has recently been proposed by Fischer, in which glucose is used as the equivalent of dextrose and fructose as the proper name for levulose. All sugars are further classified by Fischer into groups according to the number of carbon atoms found in the molecule. We have thus trioses, tetroses, pentoses, hexoses, etc. Such a sugar as sucrose is called hexobiose by reason of the fact that it appears to be formed of two molecules of hexose sugars. For a similar reason raffinose would belong to the hexotriose group.[24]
Again, the two great classes of sugars as determined by the structure of the molecule are termed aldoses and ketoses according to their relationship to the aldehyd or ketone bodies.
Since sugars may be optically twinned, that is composed of equal molecules of right and left-handed polarizing matter it may happen that apparently the same body may deflect the plane of polarization to the right, to the left, or show perfect neutrality.
Natural sugars, as a rule, are optically active, but synthetic sugars being optically twinned are apt to be neutral to polarized light.
To designate the original optical properties of the body therefore the symbols d, l, and i, meaning dextrogyratory, levogyratory, and inactive, respectively, are prefixed to the name. Thus we may have d, l, or i glucose, d, l, or i fructose, and so on.
The sugars that are of interest here belong altogether to the pentose and hexose groups; viz., C₅H₁₀O₅ and C₆H₁₂O₆, respectively. Of the hexobioses, sucrose, maltose, and lactose are the most important, [Pg 60] and of the hexotrioses, raffinose. In this manual, unless otherwise stated, the term dextrose corresponds to d glucose, and levulose to d fructose. In this connection, however, it should be noted that the levulose of nature, or that which is formed by the hydrolysis of inulin or sucrose is not identical in its optical properties with the l fructose of Fischer.
46. Preparation of Pure Sugar.—In using the polariscope or in testing solutions for the chemical analysis of samples, the analyst will be required to keep always on hand some pure sugar. Several methods of preparing pure sugar have been proposed. The finest granulated sugar of commerce is almost pure. In securing samples for examination those should be selected which have had a minimum treatment with bluing in manufacture. The best quality of granulated sugar when pulverized, washed with ninety-five per cent and then with absolute alcohol and dried over sulfuric acid at a temperature not exceeding 50° will be found nearly pure. Such a sugar will, as a rule, not contain more than one-tenth per cent of impurities, and can be safely used for all analytical purposes. It is assumed in the above that the granulated sugar is made from sugar cane.
Granulated beet sugars may contain raffinose and so may show a polarization in excess of 100. This sugar may be purified by dissolving seventy parts by weight in thirty parts of water. The sugar is precipitated by adding slowly an equal volume of ninety-six per cent alcohol with constant stirring, the temperature of the mixture being kept at 60°. While still warm the supernatant liquor is decanted and the precipitated sugar washed by decantation several times with strong warm alcohol. The sugar, on a filter, is finally washed with absolute alcohol and dried in a thin layer over sulfuric acid at from 35° to 40°. By this process any raffinose which the sugar may have contained is completely removed by the warm alcohol. Since beet sugar is gradually coming into use in this country it is safer to follow the above method with all samples.[25] In former times it was customary to prepare pure sugar from the whitest crystals of rock candy. These crystals are powdered, dissolved in water, filtered, precipitated with alcohol, washed and dried in the manner described above. [Pg 61]
47. Classification of Methods.—In the quantitive determination of pure sugar the various processes employed may all be grouped into three classes. In the first class are included all those which deduce the percentage of sugar present from the specific gravity of its aqueous solution. The accuracy of this process depends on the purity of the material, the proper control of the temperature, and the reliability of the instruments employed. The results are obtained either directly from the scale of the instruments employed or are calculated from the arbitrary or specific gravity numbers observed. It is evident that any impurity in the solution would serve to introduce an error of a magnitude depending on the percentage of impurity and the deviation of the density from that of sugar. The different classes of sugars, having different densities in solution, give also different readings on the instruments employed. It is evident, therefore, that a series of tables of percentages corresponding to the specific gravities of the solutions of different sugars would be necessary for exact work. Practically, however, the sugar which is most abundant, viz., sucrose, may be taken as a representative of the others and for rapid control work the densimetric method is highly useful.
In the second class of methods are grouped all those processes which depend upon the property of sugar solutions to rotate the plane of polarized light. Natural sugars all have this property and if their solutions be found neutral to polarized light it is because they contain sugars of opposite polarizing powers of equal intensity. Some sugars turn the polarized plane to the right and others to the left, and the degree of rotation in each case depends, at equal temperatures and densities of the solutions, on the percentages of sugars present. In order that the optical examination of a sugar may give correct results the solution must be of a known density and free of other bodies capable of affecting the plane of polarized light. In the following paragraphs an attempt will be made to give in sufficient detail the methods of practice of these different processes in so far as they are of interest to the agricultural analyst. The number of variations, however, in these processes is so great as to make the attempt to fully discuss them here impracticable. The searcher for [Pg 62] additional details should consult the standard works on sugar analysis.[26]
In the third class of methods are included those which are of a chemical nature based either on the reducing power which sugar solutions exercise on certain metallic salts, upon the formation of certain crystalline and insoluble compounds with other bodies or upon fermentation. Under proper conditions solutions of sugar reduce solutions of certain metallic salts, throwing out either the metal itself or a low oxid thereof. In alkaline solutions of mercury and copper, sugars exercise a reducing action, throwing out in the one case metallic mercury and in the other cuprous oxid. With phenylhydrazin, sugars form definite crystalline compounds, quite insoluble, which can be collected, dried and weighed. There is a large number of other chemical reactions with sugars such as their union with the earthy bases, color reactions with alkalies, oxidation products with acids, and so on, which are of great use qualitively and in technological processes, but these are of little value in quantitive determinations.
48. Principles of the Method.—This method of analysis is applied almost exclusively to the examination of one kind of sugar, viz., the common sugar of commerce. This sugar is derived chiefly from sugar cane and sugar beets and is known chemically as sucrose or saccharose. The method is accurate only when applied to solutions of pure sucrose which contain no other bodies. It is evident however, that other bodies in solution can be determined by the same process, so that the principle of the method is broadly applicable to the analyses of any body whatever in a liquid state or in solution. Gases, liquids and solids, in solution, can all be determined by densimetric methods.
Broadly stated the principle of the method consists in determining the specific gravity of the liquid or solution, and thereafter taking the percentage of the body in solution from the corresponding specific gravity in a table. These tables are carefully prepared by gravimetric [Pg 63] determinations of the bodies in solution of known densities, varying by small amounts and calculation of the percentages for the intervening increments or decrements of density. This tabulation is accomplished at definite temperatures and the process of analysis secured thereby is rapid and accurate, with pure or nearly pure solutions.
49. Determination of Density.—While not strictly correct from a physical point of view, the terms density and specific gravity are here used synonymously and refer to a direct comparison of the weights of equal volumes of pure water and of the solution in question, at the temperature named. When not otherwise stated, the temperature of the solution is assumed to be 15°.5.

Figure 27. Common Forms of Pyknometers.
The simplest method of determining the density of a solution is to get the weight of a definite volume thereof. This is conveniently accomplished by the use of a pyknometer. A pyknometer is any vessel [Pg 64] capable of holding a definite volume of a liquid in a form suited to weighing. It may be a simple flask with a narrow neck distinctly marked, or a flask with a ground perforated stopper, which, when inserted, secures always the same volume of liquid contents. A very common form of pyknometer is one in which the central stopper carries a thermometer and the constancy of volume is secured by a side tubulure of very small or even capillary dimensions, which is closed by a ground glass cap.
The apparatus may not even be of flask form, but assume a quite different shape as in Sprengel’s tube. Pyknometers are often made to hold an even number of cubic centimeters, but the only advantage of this is in the ease of calculation which it secures. As a rule, it will be found necessary to calibrate even these, and then the apparent advantage will be easily lost. A flask which is graduated to hold fifty cubic centimeters, may, in a few years, change its volume at least slightly, due to molecular changes in the glass. Some of the different forms of pyknometers are shown in the accompanying figures.
In use the pyknometer should be filled with pure water of the desired temperature and weighed. From the total weight the tare of the flask and stopper, weighed clean and dry, is to be deducted. The remainder is the weight of the volume of water of the temperature noted, which the pyknometer holds. The weight of the solution under examination is taken in the same way and at the same temperature, and thus a direct comparison between the two liquids is secured.
| Example.—Let the weight of the pyknometer be | 15.2985 | grams. |
| and its weight with pure water at 15°.5 be | 26.9327 | ” |
| Then the weight of water is | 11.6342 | ” |
| The weight filled with the sugar solution is | 28.3263 | ” |
| Then the weight of the sugar solution is | 13.0278 | ” |
The specific gravity of the sugar solution is therefore, 13.0278 ÷ 11.6342 = 1.1198.
For strictly accurate results the weight must be corrected for the volume of air displaced, or in other words, be reduced to weights in vacuo. This however is unnecessary for the ordinary operations of agricultural analysis. [Pg 65]
If the volume of the pyknometer be desired, it can be calculated from the weight of pure water which it holds, one cubic centimeter of pure water weighing one gram at 4°.
The weights of one cubic centimeter of water at each degree of temperature from 1° to 40°, are given in the following table:
Table Showing Weights of One
Cubic Centimeter of Pure Water
at Temperatures Varying from
1° To 40°.
| Temperature. | Weight, Gram. |
Temperature. | Weight, Gram. |
|---|---|---|---|
| 0° | 0.999871 | 21° | 0.998047 |
| 1° | 0.999928 | 22° | 0.997826 |
| 2° | 0.999969 | 23° | 0.997601 |
| 3° | 0.999991 | 24° | 0.997367 |
| 4° | 1.000000 | 25° | 0.997120 |
| 5° | 0.999990 | 26° | 0.996866 |
| 6° | 0.999970 | 27° | 0.996603 |
| 7° | 0.999933 | 28° | 0.998331 |
| 8° | 0.999886 | 29° | 0.995051 |
| 9° | 0.999824 | 30° | 0.995765 |
| 10° | 0.999747 | 31° | 0.995401 |
| 11° | 0.999655 | 32° | 0.995087 |
| 12° | 0.999549 | 33° | 0.994765 |
| 13° | 0.999430 | 34° | 0.994436 |
| 14° | 0.999299 | 35° | 0.994098 |
| 15° | 0.999160 | 36° | 0.993720 |
| 16° | 0.999002 | 37° | 0.993370 |
| 17° | 0.998841 | 38° | 0.993030 |
| 18° | 0.998654 | 39° | 0.992680 |
| 19° | 0.998460 | 40° | 0.992330 |
| 20° | 0.998259 |
From the table and the weight of water found, the volume of the pyknometer is easily calculated.
Example.—Let the weight of water found be 11.72892 grams, and the temperature 20°. Then the volume of the flask is equal to 11.72892 ÷ 0.998259, viz., 11.95 cubic centimeters.
50. Use of Pyknometer at High Temperatures.—It is often found desirable to determine the density of a liquid at temperatures above that of the laboratory, e. g., at the boiling-point of water. This is easily accomplished by following the directions given below:
Weight of Flask.—Use a small pyknometer of from twenty-five to thirty cubic centimeters capacity. The stopper should be beveled to a [Pg 66] fine edge on top and the lower end should be slightly concave to avoid any trapping of air. The flask is to be thoroughly washed with hot water, alcohol and ether, and then dried for some time at 100°. After cooling in a desiccator the weight of the flask and stopper is accurately determined.[27]

Figure 28. Bath for Pyknometers.
[Pg 67] Weight of Water.—The flask in an appropriate holder, Fig. 28, conveniently made of galvanized iron, is filled with freshly boiled and hot distilled water and placed in a bath of pure, very hot distilled water, in such a way that it is entirely surrounded by the liquid with the exception of the top.
The water of the bath is kept in brisk ebullition for thirty minutes, any evaporation from the flask being replaced by the addition of boiling distilled water. The stopper should be kept for a few minutes before use in hot distilled water and is then inserted, the flask removed, wiped dry, and, after it is nearly cooled to room temperature, placed in the balance and weighed when balance temperature is reached. A convenient size of holder will enable the analyst to use eight or ten flasks at once. The temperature at which water boils in each locality may also be determined; but unless at very high altitudes, or on days of unusual barometric disturbance the variations will not be great, and will not appreciably affect the results.
51. Alternate Method of Estimating the Weight of Water in Flasks.—Formulas for calculating the volume V, in cubic centimeters, of a glass vessel from the weight P of water at the temperature t contained therein, and the volume Vʹ at any other temperature t’ are given by Landolt and Börnstein.[28] They are as follows:
| V = P | p |
| d |
| Vʹ = P | p | [1 + γ (tʹ- t)]; |
| d |
in which p = weight (in brass weights) of one cubic centimeter H₂O in vacuo. This is so nearly one gram that it will not affect the result in the fifth place of decimals and may therefore be disregarded. Hence the formula stands:
| Vʹ = P | 1 | [1 + γ (tʹ- t)] |
| d |
d = density of water at temperature t.
γ = 0.000025, the cubical expansion coefficient of glass.
From this volume the weight of the water may be readily obtained by referring to tables 13, 14 and 15a in Landolt and Börnstein’s book. [Pg 68]
52. Example Showing Determination of Specific Gravity of a Fat.—The flask is emptied of its water, rinsed with alcohol and ether, and dried again for a few minutes at 100°. It is then filled with the dry, hot, fresh-filtered fat, which should be entirely free from air bubbles.
The stoppered flask is then replaced in the water-bath, kept for thirty minutes at the temperature of boiling water, removed, and treated as above. The weight of fat having been determined, the specific gravity is obtained by dividing it by the weight of water previously found.
| Example. | |
| Grams. | |
| Weight of flask, dry | 10.0197 |
| Weight of flask, plus water | 37.3412 |
| Weight of water | 27.3215 |
| Weight of flask, plus fat | 34.6111 |
| Weight of fat | 24.5914 |
| Specific gravity = 24.5914 ÷ 27.3215 = | 0.90008. |
The weight of the flask dry and empty and the weight of water at 99° to 100° contained therein may be used constantly if great care be taken in handling and cleaning the apparatus.
| Example. | |
| Grams. | |
| Weight of flask, dry and empty | 10.0028 |
| Weight of flask after three weeks’ use | 10.0030 |

Figure 29. Aereometers, Pyknometers, and Hydrostatic Balance.
53. Determination of Density by the Hydrostatic Balance.—While the pyknometer is useful in control work and in fixing standards of comparison, it is not used extensively in practical work. Quicker methods of determination are desired in such work, and these are found in the use of other forms of apparatus. A convenient method of operation consists in determining the weight of a sinker, whose exact [Pg 69] weights in air and in pure water of a definite temperature, have been previously determined. The instrument devised by Mohr and modified by Westphal, is based upon that principle, and is extensively used in practical work. The construction of this apparatus and also that of the pyknometers and areometers is shown in the illustrations, figures 29 and 30.

Figure 30. Hydrostatic Balance.
The weight of the sinker is so adjusted that the index of the balance arm marks zero when the sinker is wholly immersed in pure water at the standard temperature. The density of a solution of sugar at the same temperature, is then determined by placing the rider-weights on the [Pg 70] divided arm of the balance, until the index again marks zero. The density can then be read directly from the position of the weights in the arm of the balance or calculated therefrom.
54. The Areometric Method.—The most rapid method of determining the density of a solution and the one in most common use, is based on the distance to which a heavy bulb with a slender graduated stem will sink therein. An instrument of this kind is called an areometer. Many forms of this instrument are employed but they all depend on the same principle and differ only in the manner of graduation. The one of widest application has the stem graduated in such a manner as to give directly the specific gravity of the solution in which it is placed.
Others are made with a special graduation giving directly the percentage of solid matter in the solution. These instruments can be used only for the special purposes for which they are constructed. Other forms are provided with an arbitrary graduation, the numbers of which by appropriate tables can be converted into expressions of specific gravity or of per cents of dissolved matters. It is not practicable to give here, a discussion of the principles of the construction of areometers.[29] The two which are commonly used, are the baumé hydrometer and the balling or brix spindle.
In the baumé instrument the zero of the scale is fixed at the point marked by the surface of distilled water at 15°, and the point to which it sinks in pure monohydrated sulfuric acid at the same temperature is marked 66, corresponding to a specific gravity of 1.8427.
The specific gravity corresponding to any degree of the scale, may be calculated in the absence of a table giving it, by the following formula
| P = | 144.3 | . |
| 144.3 - d |
In this formula P is the density and d the degree of the scale.[30] In former times the baumé instruments were graduated with a solution of common salt and a different formula was employed for calculating specific gravity, but these older instruments are no longer in common use.
The following table shows the specific gravities of solutions corresponding to baumé degrees from 1° to 75° consecutively[31]:
| Degree baumé |
Specific gravity |
Degree baumé |
Specific gravity |
Degree baumé |
Specific gravity |
Degree baumé |
Specific gravity |
|---|---|---|---|---|---|---|---|
| 0 | 1.0000 | 19 | 1.1516 | 38 | 1.3574 | 57 | 1.6527 |
| 1 | 1.0069 | 20 | 1.1608 | 39 | 1.3703 | 58 | 1.6719 |
| 2 | 1.0140 | 21 | 1.1702 | 40 | 1.3834 | 59 | 1.6915 |
| 3 | 1.0212 | 22 | 1.1798 | 41 | 1.3968 | 60 | 1.7115 |
| 4 | 1.0285 | 23 | 1.1895 | 42 | 1.4104 | 61 | 1.7321 |
| 5 | 1.0358 | 24 | 1.1994 | 43 | 1.4244 | 62 | 1.7531 |
| 6 | 1.0433 | 25 | 1.2095 | 44 | 1.4386 | 63 | 1.7748 |
| 7 | 1.0509 | 26 | 1.2197 | 45 | 1.4530 | 64 | 1.7968 |
| 8 | 1.0586 | 27 | 1.2301 | 46 | 1.4678 | 65 | 1.8194 |
| 9 | 1.0665 | 28 | 1.2407 | 47 | 1.4829 | 66 | 1.8427 |
| 10 | 1.0744 | 29 | 1.2514 | 48 | 1.4983 | 67 | 1.8665 |
| 11 | 1.0825 | 30 | 1.2624 | 49 | 1.5140 | 68 | 1.8909 |
| 12 | 1.0906 | 31 | 1.2735 | 50 | 1.5301 | 69 | 1.9161 |
| 13 | 1.0989 | 32 | 1.2849 | 51 | 1.5465 | 70 | 1.9418 |
| 14 | 1.1074 | 33 | 1.2964 | 52 | 1.5632 | 71 | 1.9683 |
| 15 | 1.1159 | 34 | 1.3081 | 53 | 1.5802 | 72 | 1.9955 |
| 16 | 1.1246 | 35 | 1.3201 | 54 | 1.5978 | 73 | 2.0235 |
| 17 | 1.1335 | 36 | 1.3323 | 55 | 1.6157 | 74 | 2.0523 |
| 18 | 1.1424 | 37 | 1.3447 | 56 | 1.6340 | 75 | 2.0819 |
55. Correction for Temperature.—The baumé hydrometer should be used at the temperature for which it is graduated, usually 15°. In this country the mean temperature of our working rooms is above 15°. The liquid in the hydrometer flask should therefore be cooled to a trifle below 15°, or kept in a bath exactly at 15° while the observation is made. When this is not convenient, the observation may be made at any temperature, and the reading corrected as follows: When the temperature is above 15° multiply the difference between the observed temperature and fifteen, by 0.0471 and add the product to the observed reading of the baumé hydrometer; when the temperature on the other hand, is below fifteen, the corresponding product is subtracted.[32]
56. The Balling or Brix Hydrometer.—The object of the balling or brix instrument is to give in direct percentages the solid matter in solution. It is evident that for this purpose the instrument must be graduated for a particular kind of material, since ten per cent of sugar in solution, might have a very different specific gravity from a similar quantity of another body. Instruments of this kind graduated for pure sugar, find a large use in technical sugar analysis. To attain [Pg 72] a greater accuracy and avoid an instrument with too long a stem, the brix hydrometers are made in sets. A convenient arrangement is to have a set of three graduated as follows; one from 0° to 30°, one from 25° to 50°, and one from 45° to 85°. When the percentage of solid matter dissolved is over seventy the readings of the scale are not very reliable.
57. Correction for Temperature.—The brix as the baumé scale is graduated at a fixed temperature. This temperature is usually 17°.5. The following table shows the corrections to be applied to the scale reading when made at any other temperature:[33]
Per Cent of Sugar in Solution.
| 0. | 5. | 10. | 15. | 20. | 25. | 30. | 35. | 40. | 50. | 60. | 70. | 75. | |
| Temp. | To be subtracted from the degree read. | ||||||||||||
| 0° | 0.17 | 0.30 | 0.41 | 0.52 | 0.62 | 0.72 | 0.82 | 0.92 | 0.98 | 1.11 | 1.22 | 1.25 | 1.29 |
| 5° | 0.23 | 0.30 | 0.37 | 0.44 | 0.52 | 0.59 | 0.65 | 0.72 | 0.75 | 0.80 | 0.88 | 0.91 | 0.94 |
| 10° | 0.20 | 0.26 | 0.29 | 0.33 | 0.36 | 0.39 | 0.42 | 0.45 | 0.48 | 0.50 | 0.54 | 0.58 | 0.61 |
| 11° | 0.18 | 0.23 | 0.26 | 0.28 | 0.31 | 0.34 | 0.36 | 0.39 | 0.41 | 0.43 | 0.47 | 0.50 | 0.53 |
| 12° | 0.16 | 0.20 | 0.22 | 0.24 | 0.26 | 0.29 | 0.31 | 0.33 | 0.34 | 0.36 | 0.40 | 0.42 | 0.46 |
| 13° | 0.14 | 0.18 | 0.19 | 0.21 | 0.22 | 0.24 | 0.26 | 0.27 | 0.28 | 0.29 | 0.33 | 0.35 | 0.39 |
| 14° | 0.12 | 0.15 | 0.16 | 0.17 | 0.18 | 0.19 | 0.21 | 0.22 | 0.22 | 0.23 | 0.26 | 0.28 | 0.32 |
| 15° | 0.09 | 0.11 | 0.12 | 0.14 | 0.14 | 0.15 | 0.16 | 0.16 | 0.17 | 0.17 | 0.19 | 0.21 | 0.25 |
| 16° | 0.06 | 0.07 | 0.08 | 0.09 | 0.10 | 0.10 | 0.11 | 0.12 | 0.12 | 0.12 | 0.14 | 0.16 | 0.18 |
| 17° | 0.02 | 0.02 | 0.03 | 0.03 | 0.03 | 0.04 | 0.04 | 0.04 | 0.04 | 0.04 | 0.05 | 0.05 | 0.06 |
| To be added to the degree read. | |||||||||||||
| 18° | 0.02 | 0.03 | 0.03 | 0.03 | 0.03 | 0.03 | 0.03 | 0.03 | 0.03 | 0.03 | 0.03 | 0.03 | 0.02 |
| 19° | 0.06 | 0.08 | 0.08 | 0.09 | 0.09 | 0.10 | 0.10 | 0.10 | 0.10 | 0.10 | 0.10 | 0.08 | 0.06 |
| 20° | 0.11 | 0.14 | 0.15 | 0.17 | 0.17 | 0.18 | 0.18 | 0.18 | 0.19 | 0.19 | 0.18 | 0.15 | 0.11 |
| 21° | 0.16 | 0.20 | 0.22 | 0.24 | 0.24 | 0.25 | 0.25 | 0.25 | 0.26 | 0.26 | 0.25 | 0.22 | 0.18 |
| 22° | 0.21 | 0.26 | 0.28 | 0.31 | 0.31 | 0.32 | 0.32 | 0.32 | 0.33 | 0.34 | 0.32 | 0.29 | 0.25 |
| 23° | 0.27 | 0.32 | 0.35 | 0.37 | 0.38 | 0.39 | 0.39 | 0.39 | 0.40 | 0.42 | 0.39 | 0.36 | 0.33 |
| 24° | 0.32 | 0.38 | 0.41 | 0.43 | 0.44 | 0.46 | 0.46 | 0.47 | 0.47 | 0.50 | 0.46 | 0.43 | 0.40 |
| 25° | 0.37 | 0.44 | 0.47 | 0.49 | 0.51 | 0.53 | 0.54 | 0.55 | 0.55 | 0.58 | 0.54 | 0.51 | 0.48 |
| 26° | 0.43 | 0.50 | 0.54 | 0.56 | 0.58 | 0.60 | 0.61 | 0.62 | 0.62 | 0.66 | 0.62 | 0.58 | 0.55 |
| 27° | 0.49 | 0.57 | 0.61 | 0.63 | 0.65 | 0.68 | 0.68 | 0.69 | 0.70 | 0.74 | 0.70 | 0.65 | 0.62 |
| 28° | 0.56 | 0.64 | 0.68 | 0.70 | 0.72 | 0.76 | 0.76 | 0.78 | 0.78 | 0.82 | 0.78 | 0.72 | 0.70 |
| 29° | 0.63 | 0.71 | 0.75 | 0.78 | 0.79 | 0.84 | 0.84 | 0.86 | 0.86 | 0.90 | 0.88 | 0.80 | 0.78 |
| 30° | 0.70 | 0.78 | 0.82 | 0.87 | 0.87 | 0.92 | 0.92 | 0.94 | 0.94 | 0.98 | 0.94 | 0.88 | 0.86 |
| 35° | 1.10 | 1.17 | 1.22 | 1.24 | 1.30 | 1.32 | 1.33 | 1.35 | 1.36 | 1.39 | 1.34 | 1.27 | 1.25 |
| 40° | 1.50 | 1.61 | 1.67 | 1.71 | 1.73 | 1.79 | 1.79 | 1.80 | 1.82 | 1.83 | 1.78 | 1.69 | 1.65 |
| 50° | — | 2.65 | 2.71 | 2.74 | 2.78 | 2.80 | 2.80 | 2.80 | 2.80 | 2.79 | 2.70 | 2.56 | 2.51 |
| 60° | — | 3.87 | 3.88 | 3.88 | 3.88 | 3.88 | 3.88 | 3.88 | 3.90 | 3.82 | 3.70 | 3.43 | 3.41 |
| 70° | — | — | 5.18 | 5.20 | 5.14 | 5.13 | 5.10 | 5.08 | 5.06 | 4.90 | 4.72 | 4.47 | 4.35 |
| 80° | — | — | 6.62 | 6.59 | 6.54 | 6.16 | 6.38 | 6.30 | 6.26 | 6.06 | 5.82 | 5.50 | 5.33 |
[Pg 73] According to observations of Gerlach, the correction for temperature varies with the concentration of the solution and the range of temperature as shown in the table.
58. Comparison of Brix and Baumé Degrees.—The following table shows the degree baumé and the specific gravity of a sugar solution for each degree brix (per cent of sugar in solution) from zero to ninety-five:[34]
59. Error Due to Impurities.—The fact that equal per cents of solid bodies in solution affect the specific gravity in different degrees has already been noted. The specific gravities of the solutions of the common sugars, however, are so nearly the same for equal per cents of solid matter in solution as to render the use of a brix hydrometer quite general for technical purpose. For the mineral salts which often occur in sugar solutions the case is quite different. A twenty per cent solution of cane sugar at 17°.5 has a specific gravity 1.08329 and of dextrose 1.08310, practically identical. But a solution of calcium acetate of similar strength has a specific gravity of 1.0874; of sodium sulfate 1.0807, and of potassium nitrate 1.1359. This latter number would correspond to a sugar content of nearly twenty-seven per cent. The brix scale can, therefore, be regarded as giving only approximately the percentage of solid matter in sugar solutions and, while useful in technical work, should never be relied upon for exact analytical data.
60. Optical Properties of Natural Sugars.—The solutions of all natural sugars have the property of deflecting the plane of polarized light and the degree of deflection corresponds to the quantity of sugar in solution. By measuring the amplitude of the rotation produced the percentage of sugar in the solution can be determined. In order to secure accuracy in the determinations it is necessary that only one kind of sugar be present, or, if more than one, that the quantities of all but one be determined by other means, and the disturbances produced [Pg 75] thereby in the total rotation be properly arranged. In point of fact the process in practice is applied chiefly to cane and milk sugars, both of which occur in nature in an approximately pure state. The process is also useful in determining cane sugar when mixed with other kinds, by reason of the fact that this sugar after hydrolysis by treatment with a weak acid for a long or a strong acid for a short time, definitely changes its rotating power. Since, by the same treatment, the rotating power of other sugars which may be present is only slightly altered, the total disturbance produced is approximately due to the inversion of the cane sugar.
Dextrose and maltose arising from the hydrolysis of starch may also be determined with a fair degree of accuracy by their deportment with polarized light. When a solution of natural sugars shows negative results when examined with polarized light, it is due to an admixture of two or more sugars of opposite polarizing powers in such proportions as to produce neutrality. This condition often occurs in the examination of honeys or in submitting artificial sugars to polarimetric observations. In the latter case the neutrality is caused by the tendency manifested by artificially produced sugars to form twin compounds of optically opposite qualities.
The instrument used for measuring the degree of deflection produced in a plane of polarized light is called a polariscope, polarimeter, or optical saccharimeter. For a theoretical discussion of the principles of polarization and the application of these principles in the construction of polariscopes, the reader is referred to the standard works on optics and the construction of optical instruments.[35] For the purposes of this work a description of the instruments commonly employed and the methods of using them will be sufficient.
61. Polarized Light.—When a ray of light has been repeatedly reflected from bright surfaces or when it passes through certain crystalline bodies it acquires peculiar properties and is said to be polarized.
Polarization is therefore a term applied to a phenomenon of light, in which the vibrations of the ether are supposed to be restricted to a [Pg 76] particular form of an ellipse whose axes remain fixed in direction. If the ellipse become a straight line it is called plane polarization. This well-known phenomenon is most easily produced by a nicol prism, consisting of a cut crystal of calcium carbonate (Iceland spar). This rhombohedral crystal, the natural ends of which form angles of 71° and 109°, respectively, with the opposite edges of its principal section, is prepared as follows:
The ends of the crystals are ground until the angles just mentioned become 68° and 112°. The crystal is then divided diagonally at right angles with the planes of the ends and with the principal section, and after the new surfaces are polished they are joined again by canada balsam. The principal section of this prism passes through the shorter diagonal of the two rhombic ends. If now a ray of light fall on one of the ends of this prism, parallel with the edge of its longer side, it suffers double refraction, and each ray is plane polarized, the one at right angles with the other. That part of the entering ray of light which is most refracted is called the ordinary and the other the extraordinary ray. The refractive index of the film of balsam being intermediate between those of the rays, permits the total reflection of the ordinary ray, which, passing to the blackened sides of the prism, is absorbed. The extraordinary ray passes the film of balsam without deviation and emerges from the prism in a direction parallel with the incident ray, having, however, only half of its luminous intensity.
Two such prisms, properly mounted, furnish the essential parts of a polarizing apparatus. They are called the polarizer and the analyzer, respectively.
If now the plane of vibration in each prism be regarded as coincident with its principal section, the following phenomena are observed: If the prisms are so placed that the principal sections lie in the prolongation of the same plane, then the extraordinary polarized ray from the polarizer passes into the analyzer, which practically may be regarded in this position as a continuation of the same prism. It happens, therefore, that the extraordinary polarized ray passes through the analyzer exactly as it did through the polarizer, and is not reflected by the film of balsam, but emerges from the analyzer in [Pg 77] seemingly the same condition as from the polarizer. If now the analyzer be rotated 180°, bringing the principal section again in the same plane, the same phenomenon is observed. But if the rotation be in either direction only 90°, then the polarized ray from the first prism, incident on the second, deports itself exactly as the ordinary ray, and on meeting the film of balsam is totally reflected. The field of vision, therefore, is perfectly dark.
In all other inclinations of the planes of the principal sections of the two prisms the ray incident in the analyzer is separated into two, an ordinary and extraordinary, varying in luminous intensity in proportion to the square of the cosine of the angle of the two planes.

Figure 31. Course
of Rays of Light
In a Nicol.
Thus, by gradually turning the analyzer, the field of vision passes slowly from maximum luminosity to complete obscurity. The expression crossed nicols refers to the latter condition of the field of vision.
62. Description of the Prism.—In a nicol made as described above, Fig. 31, suppose a ray of light parallel with the longer side of the prism be incident to the end a b at m. By the double refracting power of the spar the ray is divided into two, which traverse the first half of the prism. The two rays are polarized at right angles to one another. The less refracted ray when it strikes the film of Canada balsam passes through it without interference. The more refracted ray strikes the balsam at o at such an angle as to be totally reflected and made to pass out of the prism in the direction [Pg 78] o r. If the prism be blackened at the surface the ray will be entirely absorbed. The other ray passes on through the other half of the prism and emerges in the direction of qs. It is evident that the emergent light from a nicol has only half the illuminating power possessed by the immergent rays.
The polarized plane of light from the nicol just described may be regarded as passing also into a second nicol of essentially the same construction as the first.
This second nicol, called the analyzer, is so constructed as to revolve freely about its longitudinal axis, and is attached to a graduated circle in such a way that the degree of rotation can be accurately read. If the planes of polarization of the two nicols are coincident when prolonged, the ray of light passing from the first nicol will pass through the second practically unchanged in character or intensity. If, however, the analyzing nicol be turned until the plane of polarization is at right angles to that of the polarizer the immergent ray will suffer refraction in such a manner as to be totally reflected when reaching the film of balsam and will be thus entirely lost. In making a complete revolution of the analyzer, therefore, two positions of maximum intensity of light and two of darkness will be observed. In intermediate positions the ray immergent to the analyzer will be separated as in the first instance into two rays g p varying intensities, one of which will be always totally reflected.

Figure 32. Theory of
the Nicol.
In Fig. 32 is given a more detailed illustration of the action of the rays of light. The film of balsam is represented as enlarged and of the thickness bb. Draw the perpendiculars represented by the dotted lines n₁ nʹ₁, n₂ nʹ₂, n₃ nʹ₃ and n₄ nʹ₄. In passing into the prism at m both [Pg 79] refracted rays are bent towards the normal m nʹ₁. The degree of deflection depends on the refractive index of the two rays 1.52 and 1.66 respectively. The refractive index of the extraordinary ray in calcspar being 1.52, and in Canada balsam 1.54, it suffers but little disturbance in passing from one to the other. On the other hand the balsam, being considerably less refractive for the ordinary ray than the calcspar, causes that ray to diverge outwards from the normal o nʹ₂, and to such a degree as to suffer total reflection. The critical angle, that is the angle at which a ray issuing from a more refractive into a less refractive medium, emerges just parallel to the bounding surfaces, depends on the relative index of refraction. In the case under consideration the ratio for balsam and spar is 1.54/1.66 = 0.928 = sin 68°. Therefore the limiting value of m o n₃ so that m o may just emerge in the direction od is 68°. If now mo were parallel to o d the angle m o n, would be just 68°, being opposite b a d. which has been ground to 68° in the construction of the prism. But in passing into the prism, m o is refracted so that the angle m o n₃ is greater than b a d. It is therefore always certain that by grinding b a d to 68° the ordinary ray m o will be with certainty entirely thrown out in every case. In respect of the analyzing nicol the following additional observations will be found useful. In all uniaxial crystals there are two directions at right angles to each other, one of greatest and one of least resistance to the propagation of luminous vibrations. These planes are in the direction of the principal axis and at right angles thereto. Only light vibrating in these two directions can be transmitted through calcspar; and all incident light propagated by vibrations in a plane at any other angle to the principal section is resolved into two such component rays. But the velocities of transmission in the two directions are unequal, that is, the refractive index of the spar for the two rays is different. If the analyzing nicol be so adjusted as to receive the emergent light from the polarizer when the corresponding planes of the two prisms are coincident when extended, the emergent extraordinary ray falling into a plane of the same resistance as that it had just left is propagated through the second nicol with the same velocity that it passed the [Pg 80] first one. It is therefore similarly refracted. If, however, the two prisms be so arranged that corresponding planes cross then the extraordinary ray falls into a plane which it traverses with greater velocity than it had before and is accordingly refracted and takes the course which ends in total reflection at the film of balsam. No light therefore can pass through the prism in that position. If any other substance, as for instance a solution of sugar, capable of rotating a plane of polarized light, be interposed between the two nicols the effect produced is the same as if the analyzer had been turned to a corresponding degree. When the analyzer is turned to that degree the corresponding planes again coincide and the light passes. This is the principle on which the construction of all polarizing instruments is based.[36]
63. The Polariscope.—A polariscope for the examination of solutions of sugar consists essentially of a prism for polarizing the light, called a nicol, a tube of definite length for holding the sugar solution, a second nicol made movable on its axis for adjustment to the degree of rotation and a graduated arc for measuring it. Instead of having the second nicol movable, many instruments have an adjusting wedge of quartz of opposite polarizing power to the sugar, by means of which the displacement produced on the polarized plane is corrected. A graduated scale and vernier serve to measure the movement of the wedges and give in certain conditions the desired reading of the percentage of sugar present. Among the multitude of instruments which have been devised for analytical purposes, only three will be found in common use, and the scope of this volume will not allow space for a description of a greater number. For a practical discussion of the principles of polarization and their application to optical saccharimetry, the reader may conveniently refer to the excellent manuals of Sidersky, Tucker, Landolt, and Wiechmann.[37]
64. Kinds of Polariscopes.—The simplest form of a polarizing apparatus consists of two nicol prisms, one of which, viz., the analyzer, is capable of rotation about its long axis. The prolongation of this axis is continuous with that of the other prism, viz., the polarizer. The two prisms are sufficiently removed from each other to allow of the interposition of the polarizing body whose rotatory power is to be measured. [Pg 81]
For purposes of description three kinds of polarimeters may be mentioned.
1. Instruments in which the deviation of the plane of polarization is measured by turning the analyzer about its axis.
Instruments of this kind conform to the simple type first mentioned, and are coeteris paribus the best. The Laurent, Wild, Landolt-Lippich, etc., belong to this class.
2. Instruments in which both nicols are fixed and the direction of the plane of polarized light corrected by the interposition of a wedge of a solid polarizing body.
Belonging to this class are the apparatus of Soleil, Duboscq, Scheibler, and the compensating apparatus of Schmidt and Haensch.
3. Apparatus in which the analyzer is set at a constant angle with the polarizer, and the compensation secured by varying the length or concentration of the interposed polarizing liquid.
The apparatus of Trannin belongs to this class.
65. Appearance of Field of Vision.—Polarimeters are also classified in respect of the appearance of the field of vision.
1. Tint Instruments.—The field of vision in these instruments in every position of the nicols, except that on which the plane of vibration of the polarized light is coincident with the three principal sections, is composed of two semi-disks of different colors.
2. Shadow Instruments.—The field of vision in this class of polarimeters in all except neutral positions, is composed of two semi-disks, one dark and one yellow. As the neutral position is approximated the two disks gradually assume a light yellow color, and when neutrality is reached they appear to be equally colored.
The Laurent, Schmidt and Haensch shadow and Landolt-Lippich instruments, are of this class.
3. Striated Instruments.—In this class the field of vision is striated. The lines may be tinted as in Wild’s polaristrobometer or black, as in the Duboscq and Trannin instruments. The neutral position is indicated either by the disappearance of the striae (Wild) or by the phenomenon of their becoming continuous. (Duboscq, Trannin.) [Pg 82]
66. Character of Light Used.—Polariscopes may be further divided into two classes, based on the kind of light employed.
1. Instruments which Use Ordinary White Light.—(Oil lamp, etc.) Scheibler, Schmidt and Haensch.
2. Instruments Employing Monochromatic Light.—(Sodium flame, etc.) Laurent, Landolt-Lippich, etc.
67. Interchangeable Instruments.—Some of the instruments in common use are arranged to be used either with ordinary lamp or gas light, or with a monochromatic flame. Laurent’s polarimeter is one of this kind. The compensating instruments also may have the field of vision arranged for tints or shadows. Theoretically the best instrument would be one in which the light is purely monochromatic, the field of vision a shadow, and the compensation secured by the rotation of the second nicol.
The accuracy of an instrument depends, however, on the skill and care with which it is constructed and used. With quartz wedges properly ground and mounted, and with ordinary white light, polariscopes may be obtained which give readings as accurate as can be desired.
Since many persons are more or less affected with color-blindness, the shadow are to be preferred to the tint fields of vision.
For practical use in sugar analysis the white light is much more convenient than the monochromatic light.
For purposes of general investigation the polarimeters built on the model of the laurent are to be preferred to all others. Such instruments are not only provided with a scale which shows the percentage of sucrose in a solution, but also with a scale and vernier by means of which the angular rotation which the plane of vibration has suffered, can be accurately measured in more than one-quarter of the circle.
68. Rotation Instruments.—This instrument has already been described as one in which the extent of deviation in the plane of polarized light caused by the intervention of an optically active substance is measured by rotating one of the nicols about its axis and measuring the degree of this rotation by a vernier on a graduated arc. [Pg 83]
In Germany these instruments are called polaristrobometers, and in France polarimètrés. In England and this country the term polariscope or polarimeter is applied without discrimination to all kinds of optical saccharimeters.
The polariscope of Mitscherlich was one of the earliest in use. It has now been entirely superseded by more modern and accurate instruments.
69. The Laurent Instrument.—A polariscope adapted by Laurent to the use of monochromatic yellow light is almost exclusively used in France and to a considerable extent in this country. In case a worker is confined to the use of a single instrument, the one just mentioned is to be recommended as the best suited to general work. It has the second nicol, called the analyzer, movable and the degree of rotation produced is secured in angular terms directly on a divided circle. The scale is graduated both in angular measurements and in per cents of sugar for a definite degree of concentration of the solution and length of observation tube. The normal solution in the laurent instrument contains 16.19 grams of pure sugar in 100 true cubic centimeters, and the length of the observation tube is 200 millimeters. Both the angular rotation and the direct percentage of sugar can be read at the same time. Great accuracy can be secured by making the readings in each of the four quadrants. The light is rendered yellow monochromatic by bringing into the flames of a double bunsen, spoons made of platinum wire, which carry fragments of fused sodium chlorid.

Figure 33. Laurent Lamp.
70. The Laurent Burner.—The theory of the illumination of the laurent burner is illustrated by the accompanying Fig. 33. The lamp consists essentially of two bunsens, surmounted by a chimney.[38] A curved spoon made of platinum gauze serves to hold the fused particles [Pg 84] of sodium chlorid which are used to produce the yellow light. The spoon is shown at G, held by the arm F, fastened by the key P. The interior intense flame B B is surrounded by an exterior less highly colored flame A A. It is important that the optical axis of the polariscope be directed accurately upon the disk B, which is the most intense part of the illumination. The point of the spoon carrying the salt should be coincident with the prolongation of the lamp TT, so that it just strikes the edge of the blue flame. Care should be taken not to press the spoons into the interior of the flame as by so doing the intensity of the illumination is very much diminished. Great care must be observed in the position of the spoon G, and the platinum arm F being flexible, the operator with a little patience, will be enabled to properly place the spoon by bending it. Moreover, if the spoon be pressed too far into the flame, the melted particles of salt collecting in the bottom of G may drop into the lamp and occlude the orifices through which the gas enters. The light of the yellow flame produced by the lamp may be further purified by passing through a prism filled with a solution of potassium dichromate, or better, a homogeneous disk cut from a crystal of that salt.
Since the flame produced by the above device is not perfectly constant, being more intense at the moment of introducing a fresh portion of the fused salt, the author has used a lamp designed to furnish an absolutely constant flame.[39] This device which is shown in Fig. 34, is based on the principle of adding constantly a fresh portion of the salt to the flame. The flame is thus kept perfectly uniform in its intensity.
The lamp consists essentially of two wheels with platinum gauze perimeters and platinum wire spokes, driven by a clock-work D, and mounted by the supports AAʹ as shown in the figure. The sodium salt, chlorid or bromid, in dilute solution, is placed in the porcelain crucibles F, supported by BBʹ as indicated in the figure, to such a depth that the rims of the platinum wheels dip beneath the surface as they revolve. The salt is volatilized by the lamp E. By means of the crossed bands the wheels are made to revolve in opposite directions as indicated by the arrows. The solution of the salt which is taken up by [Pg 85] the platinum net-work of the rim of the wheel, thus has time to become perfectly dry before it enters the flame and the sputtering which a moist salt would produce is avoided. At every instant, by this arrangement, a minute fresh portion of salt is introduced into the flame with the result of making a perfectly uniform light which can be used for hours without any perceptible variation. The mechanism of the apparatus is so simple that no further description is necessary. The polariscope should be so directed toward the flame as to bring into the field of vision its most luminous part. The platinum wheels are adjustable and should be so arranged as to produce between them an unbroken yellow flame. The wheels are eight centimeters in diameter and are driven at a rate to make one revolution in from six to ten minutes.

Figure 34. Lamp for Producing Constant
Monochromatic Flame.
[Pg 86] 71. Construction of Laurent’s Apparatus.—The shadow polariscope invented by Laurent is constructed as follows: The polarizer is a special nicol which is not fixed in its position, but is so arranged as to be turned through a small arc about its axis. By this device, the quantity of light passing through it can be regulated, and the apparatus is thus useful with colored solutions which are not easily cleared by any of the common bleaching agents. The greater the quantity of light admitted, however, the less delicate is the reading of the shadow produced. The plane of polarized light emergent from this prism, falls on a disk of glass half covered by a thin lamina of quartz which thus divides the field of vision into halves. It is this semi-disk of quartz which is the distinguishing feature of the apparatus.[40] The polarized light thus passes without hindrance the half field of vision which is covered by the glass only, but can not pass the quartz plate unless its axis is set in a certain way. The field of vision may be thus half dark, or both halves may be equally illuminated or equally dark according to the position of the nicol analyzer which is freely movable about its axis and carries a vernier and reading glass over a graduated circle. The field of vision in the laurent may have any of the following forms.[41] Let the polarizer be first so adjusted that the plane of polarization of the transmitted pencil of light is parallel to the axis of the plate lying in the direction A B. The two halves of the field of vision will then appear equally illuminated in every position of the analyzer. But if the polarizing nicol be inclined to AB at an angle a, the plane of polarization of the rays passing through the quartz plate will undergo deviation through an equal angle in the opposite direction.

Figure 35. Field of Vision of a Laurent Polariscope.
[Pg 87] It happens from this, that when in the uncovered half of the field, the plane of polarization has the direction AC, in the other half it will have the direction ACʹ. When the analyzer is rotated, if its plane of polarization lie in the direction cc, the rays polarized parallel to AC will be completely extinguished and the corresponding half of the field will be dark. The opposite happens when the plane of polarization lies in the direction of cʹcʹ. When one-half of the field is thus obscured, the other suffers only a partial diminution in the intensity of its illumination. When the middle position bb is reached in the rotation of the analyzer, the illumination of the two halves is uniform, and this is the point at which the zero of the scale is reached. The slightest rotation of the analyzer to the right or left of this neutral point will cause a shadow to appear on one of the halves of the field, which by an oscillatory movement of the analyzer, seems to leap from side to side. The smaller the angle a or BAC, the more delicate will be the shading and the more accurate the observation. This angle being adjustable by the mechanism already described, should be made as small as will permit the admission of the quantity of light requisite for accurate observation.
The various pieces composing the polariscope are arranged in the following positions, beginning on the right of Fig. 36, and passing to the left, where the observer is seated.[42]
1. The lamp VV, TT, AA, or the wheel burner:
2. The lens B for condensing the rays and rendering them parallel:
3. The tube I, blackened inside to carry the lens:
4. A thin lamina E, cut from a crystal of potassium bichromate, serving to render the sodium light more monochromatic: When the saccharine liquids under examination are colored the crystal of bichromate is removed before the observation is made.
5. The polarizer R, which is rotatable through a small angle by the lever K:
6. The lever JK for rotating the tube containing the polarizer: This is operated by the rod X extending to the left.
7. Diaphragm D, half covered with a lamina of quartz. [Pg 88]
8. Trough L for holding the observation tube: In the large instrument shown in the figure, it is more than half a meter in length and arranged to hold an observation tube 500 millimeters long.
9. Disk C, carrying divided circle and arbitrary sugar scale:
10. Mirror M, to throw the light of the lamp on the vernier of the scale:

Figure 36. Laurent Polariscope.
11. Reading glass N, carried on the same radius as the mirror and used to magnify and read the scale:
12. Device F, to regulate the zero of the instrument:
13. Tube H, carrying a nicol analyzer and ocular O for defining the field of vision: This tube is rotated by the radial arm G, carrying the mirror and reading glass.
72 Manipulation.—The lamp having been adjusted, the instrument, in a dark room, is so directed that the most luminous spot of the flame is in the line of vision. An observation tube filled with water is placed in the trough and the zero of the vernier is placed accurately on the zero of the scale. The even tint of the field of vision is then secured by adjusting the apparatus by the device number 12.
73 The Soleil-Ventzke Polariscope.—A form of polariscope giving a colored field of vision was in use in this country almost exclusively until within ten years, and is still largely employed. There are many [Pg 89] forms of tint instruments, but the one almost exclusively used here is that mentioned. A full description of their construction and manipulation is given by Tucker.[43] By the introduction of a third rotating nicol in front of the lens next to the lamp, the sensitive tint at which the reading is made can be kept at a maximum delicacy. These instruments are capable of rendering very reliable service, especially in the hands of those who have a delicate perception of color. They are inferior, however, to the shadow instruments in delicacy, and are more trying to the eye of the observer. The shadow instruments therefore, especially those making use of an ordinary kerosene lamp, have practically driven the tint polariscopes out of use.
The general arrangement of a tint instrument as modified by Scheibler is shown in Fig. 37.

Figure 37. Tint Polariscope.
Beginning on the right of the figures, its optical parts are as follows: A is a nicol which, with the quartz plate B, forms the apparatus for producing the light rose neutral tint. The proper degree of rotation of these two parts is secured by means of the button L attached to the rod carrying the ratchet wheel as shown. The polarizing nicol is at C, and D is a quartz disk, one-half of which is right-handed and the other left-handed. At G is another quartz plate belonging to the analyzing part of the apparatus. This, together with the fixed quartz wedge F, and the movable quartz wedge E, constitute the compensating apparatus of the instrument whereby the deviation produced in the plane of polarized light by the solution in the tube is restored.
Next to the compensating apparatus is the analyzing nicol which in this [Pg 90] instrument is fixed in a certain place, viz., the zero of the scale. The analyzer and the telescope for observing the field of vision are carried in the tube HJ. The movable quartz wedge has a scale which is read with a telescope K, provided with a mirror inclined at an angle of 45°, just over the scale and serving to illuminate it. The quartz wedges are also provided with a movement by which the zero point of the scale can be adjusted. A kerosene lamp with two flat wicks is the best source of illumination and the instrument should be used in a dark room and the light of the lamp, save that which passes through the polariscope, be suppressed by a shade. The sensitive or transition tint is produced by that position of the regulating apparatus which gives a field of view of such a nature that a given small movement of the quartz compensating wedge gives the greatest contrast in color between the halves of the field of vision. For most eyes a faint rose-purple tint, as nearly colorless as possible, possesses this quality. A slight movement of the quartz wedge by means of the screw head M will, with this tint, produce on one side a faint green and on the other a pink color, which are in strong contrast. The neutral point is reached by so adjusting the quartz wedge as to give to both halves of the field the same faint rose-purple tint.
74. The Shadow Polariscope for Lamp Light.—This form of instrument is now in general use for saccharimetric purposes. It possesses on the one hand, the advantages of those instruments using monochromatic light, and on the other, the ease of manipulation possessed by the tint polariscopes. It differs from the tint instrument in dispensing with the nicol and quartz plate used to regulate the sensitive tint, and in having its polarizing nicol peculiarly constructed in harmony with the optical principles of the jellet-corny prism. The more improved forms of the apparatus have a double quartz wedge compensation. The two wedges are of opposite optical properties, and serve to make the observations more accurate by mutual correction. The optical arrangement of the different parts of such a polariscope is shown in the following figure.
The lenses for concentrating the rays of light and rendering them [Pg 91] parallel are contained in the tube N. At O is placed the modified polarizing nicol. The two compensating quartz wedges are moved by the milled screw-heads EG. The rest of the optical apparatus is arranged as described under the tint polariscope. For practical purposes, only one of the wedges is employed, but for all accurate work the readings should be made with both wedges and thus every possible source of error eliminated.

Figure 38. Double Compensating Shadow Polariscope.
75. The Triple Shadow Instrument.—When properly made, all the instruments which have been mentioned, are capable of giving accurate results if used in harmony with the directions given. In the use of polariscopes having colored fields of vision a delicate sense of distinguishing between related tints is necessary to good work. Color-blind observers could not successfully use such apparatus. In the shadow instruments it is only necessary to distinguish between the halves of a field of vision unequally illuminated and to reduce this inequality to zero. A neutral field is thus secured of one intensity of illumination and of only one color, usually yellow. Such a field of vision permits of the easy discrimination between the intensity of the coloration of its two halves, and is consequently not trying to the eye of the observer, and allows of great accuracy of discrimination. This field of vision has lately been still further improved by dividing it into three parts instead of two. An instrument of this kind, Fig. 39, in use in this laboratory, permits a delicacy of reading not possessed by any other instrument used for sugar analysis, and approaching that [Pg 92] of the standard Landolt-Lippich apparatus, used by us for research work and for determining the rotation of quartz plates and testing the accuracy of other polariscopes.

Figure 39. Triple Shadow Polariscope.
The triple shadow is secured by interposing in front of the polarizing nicol two small nicols as indicated in Fig. 40. The end views in different positions of the polarizer are shown in the lower part of the diagrams.

Figure 40. Apparatus for Producing a Triple Shadow.
Instead of the comparison of the intensity of the illumination being made on the halves of the field of vision it is made by comparing the segments of the halves with a central band, which also changes in intensity synchronously with the two segments, but in an opposite direction.
76. General Principles.—Having described the instruments chiefly employed in the optical examination of sugar solutions, the next [Pg 93] step is to apply them to the analytical work. A common set of directions for use will be found applicable to all instruments with such modifications only as are required by peculiarities of construction. With the best made instruments it is always advisable to have some method of controlling the accuracy of the observation. The simplest way of doing this is to test the apparatus by standard quartz plates. These plates are made from right-handed polarizing quartz crystal ground into plates of definite thickness and accurately tested by standard instruments. Theoretically such quartz plates deflect the plane of polarized light in a degree proportionate to their thickness, but practically some small deviations from the rule are found. With a source of light of the same tint, and at a constant temperature, such plates become a safe test for the accuracy of the graduation of polariscopes. They are more convenient for use than pure sugar solutions of known strength which are the final standards in all disputed cases. These quartz plates are conveniently mounted in tubes of the same size as those holding the sugar solution, and thus fit accurately into the trough of the polariscope, the optical axis of which passes through their center. The quartz plate when used for setting the scale of a polariscope should be placed always in the same position. In some plates slight differences of reading may be noticed on rotating the tubes holding them. Theoretically, such differences should not exist, but in practice they are sometimes found. The temperature of observation should also be noted, and if not that at which the value of the plate was fixed a proper correction should be made.
77. Setting the Polariscope.—While mention has been made of several forms of apparatus in the preceding paragraphs, those in common use are limited to a very small number. In this country quite a number of color instruments may still be found, together with a few laurents, and a constantly increasing number of shadow instruments for use with lamp light. The following description of setting the polariscope is especially adapted to the last named instrument, but the principles of adjustment are equally applicable to all.
The scale of the instrument is first so adjusted by means of the adjusting screws provided with each instrument, as to bring the zero of [Pg 94] the vernier and that of the scale exactly together. The telescope or ocular is then adjusted until the sharp line separating the halves of the field of vision is brought into focus. This being accomplished an observation tube filled with pure water is placed in the apparatus and the telescope again adjusted to bring the dividing line of the field into focus. The beginner especially, should repeatedly study this adjustment and be impressed with the fact that only in a sharply defined field are practical observations of any worth. The importance of having all the lenses perfect and all the cover glasses without a flaw may be fully appreciated when it is remembered that the polarized ray, already deprived of half its original luminous power, must pass through several centimeters of crystallized calcium carbonate, and half a dozen disks of glass and quartz, and as many lenses before reaching the eye of the observer. Only with the greatest care and neatness is it possible to secure the required degree of illumination. The zero point having been well studied and accurately adjusted, the scale of the instrument may be tried with a series of quartz plates of known polarizing power at the temperature of the observation. In the apparatus with double quartz wedge compensation, it will be noticed that the marks on one scale are black and on the other red. The black is the working and the red the control scale. To operate this instrument, the red scale is placed exactly at the zero point. The black scale is also placed at zero, and if the field of vision is not neutral, it is made so by the micrometer screw with which the black scale is provided. In a right-handed solution, the red scale is left at zero and the black one moved to the right until neutrality in the field of vision is reached and the reading is taken. The observation tube containing the sugar solution is taken out and the red scale moved until the field of vision is again neutral and the reading of the red scale taken. The two readings should agree. Any failure in the agreement shows some fault either in adjusting the apparatus or in its construction, or some error in manipulation.
The double compensating shadow instruments are more readily tested for accuracy in all parts of the scale than those of any other [Pg 95] construction. The two compensating wedges are cut with the greatest care, one from a left-handed and the other from a right-handed perfectly homogeneous quartz crystal. Since faults in these wedges are due either to lack of parallelism of surface, or of perpendicularity to the optical axis of the crystal, and since these faults of crystallization or construction must be in a very limited degree common they would not coincide once in many thousand times in the two wedges. This is easily shown by the theory of probabilities. If, therefore, the two readings made at any point, should not agree, it must be due either to a fault in one of the wedges, or to a fault in reading or a lack of adjustment, as has been mentioned. In such cases the readings should be retaken and the errors are usually easily discovered.
78. Control Observation Tube.—Instead of using quartz plates of known values for testing the accuracy of the scale, an observation tube may be used, the length of which can be varied at the pleasure of the observer.
The construction of a tube of this kind is shown in Fig. 40. The tube B is movable telescopically in A by means of the ratchet wheel shown. It is closed at D water-tight by a glass disk. The tube B fits as accurately into A as is possible to permit of free movement, and any liquid which may infilter between its outer surface and the inner surface of A is prevented from gaining exit by the washer C, which fits both tubes water-tight. The ratchet which moves B in A carries a millimeter scale and vernier N whereby the exact thickness of the liquid solution between the surfaces of the glass disks D and E can be always determined.

Figure 41. Control Observation Tube.
[Pg 96] By this device the length of liquid under observation can be accurately read to a tenth of a millimeter. The cover glass E is held in position by any one of the devices in common use for this purpose in the case in question, by a bayonet fastening. The funnel T, communicating directly with the interior of A, serves to hold the solution, there being always enough of it to fill the tube when D is removed to the maximum distance from C, which is usually a little more than 200 millimeters.
Let the control tube be adjusted to 200 millimeters and filled with a solution of pure sugar, which reads 100 per cent or degrees in a 200 millimeter tube. Since the degree of rotation is, other things being equal, proportional to the length of the column of polarizing solution, it follows that if the tube B be moved inward until the distance between D and C is 100 millimeters, the scale should read 50° or per cent. By adjusting the length of the distance between B and C it is easily seen that every part of the scale can be accurately tested.
The tube should be filled by removing the funnel and closing the orifice with a screw cap which comes with the apparatus. The cap E is then removed and the tube filled in the ordinary manner. This precaution is practiced to avoid carrying air bubbles into the tube when filled directly through the funnel. With a little care, however, this danger may be avoided, or should air bubbles enter they can be easily removed by inclining the tube.
In case the solution used be not strictly pure it may still be employed for testing the scale. Suppose, for instance, that a solution made up in the usual way, has been made from a sample containing only 99.4 per cent of sugar. Then in order to have this solution read 100° on the scale the tube should be set at 201.2 millimeters, according to the formula
| 200 × 100 | = 201.2. | |
| 99.4 |
By a similar calculation the position of the tube for reading any desired degree on the scale can be determined. The importance of controlling all parts of the scale in compensating instruments is emphasized by the fact that a variation of only 0.016 millimeter in the thickness of the compensating wedge will cause a change of one degree in the reading of the instrument.
79. Setting the Polariscope with Quartz Plates.—Pure sugar is [Pg 97] not always at the command of the analyst, and it is more convenient practically to adjust the instrument by means of quartz plates, the sugar values of which have been previously tested for the character of the light used. Assuming the homogeneity of a plate of quartz, the degree of deflection which it imparts to a plane of polarized light depends on the quality of the light, the thickness of the plate, and the temperature.
In respect of the quality of light, red polarized rays are least, and violet most deflected. The degree of rotation produced with any ray, at a given temperature, is directly proportional to the thickness of the plate. Temperature affects the rotating power of a quartz plate in a degree highly significant from a scientific point of view and not wholly negligible for practical purposes. The rotating power of a quartz plate increases with the temperature and the variation may be determined by the formula given below:[44]
The formula is applicable for temperatures between 0° and 100°. Its values are expressed in degrees of angular measure which can be converted into degrees of the sugar scale by appropriate factors:
Formula.— aᵗ = a°(1 + 0.000146t);
in which a° = polarization in angular degrees at 0°, t the temperature of observation and aᵗ the rotation desired.
Example.—A quartz plate which has an angular rotation of 33° at 0° will have a rotation at 20° of 33°.09834.
aᵗ = 33(1 + 0.000146 × 20) = 33.09834.
Since in instruments using the ventzke scale one degree of the sugar scale is equal to 0.3467 degree angular measure, the sugar value of the quartz plate mentioned is equal to 95.47 percent; 33.09834 ÷ 0.3467 = 95.47.
The sugar value of this plate at 0° is 95.18 per cent; 33 ÷ 0.3467 = 95.18.
80. Tables for Correcting Quartz Plates.—Instead of calculating the variation in quartz plates for each temperature of observation, it is recommended by the Bureau of Internal Revenue of the Treasury, to use control quartz plates the values of which at any given temperature, are found on a card which accompanies each one.[45] The variations given, are from temperatures between 10° and 35°. Three control [Pg 98] plates are provided with each instrument used by the Bureau, for polarimetric work in the custom houses, or in ascertaining bounties to be paid on the production of domestic sugars. For example, the case of a sugar which polarizes 80°.5 may be cited. One of the control plates nearest to this number, is found to have at the temperature of observation, a polarization of 91°.4, the reading being made in each case at 25°. On consulting the card which accompanies the control plate, it is seen that its value at the temperature mentioned, is 91°.7. The reading of the instrument is therefore too low by three-tenths of a degree, and this quantity should be added to the observed polarization, making it 80°.8. In this method of correcting the reading for temperature, it is assumed that the compensating wedges of the instrument, are free of error at the points of observation. The plates used for the purpose above, are all standardized in the office of weights and measures of the Coast and Geodetic Survey, before delivery to the analysts.
81. Applicability of Quartz Plates.—Quartz plates which are correctly set for one instrument or kind of light, should be equally accurate for the sugar scales of all instruments, using the same sugar factor. In other words a quartz plate which reads 99° on a scheibler color polariscope, should give the same reading on the sugar scale of a shadow compensating or a monochromatic direct reading apparatus using 26.048 grams of sugar.
The most useful quartz plates for sugar analysis, are those which give the readings at points between 80° and 96°, which cover the limits of ordinary commercial sugars. For molasses the plates should read from 45° to 55°. For sugar juices of the cane and beet, the most convenient graduation would be from 10° to 20°, but plates of this value would be too thin for practical work and are not in use. When quartz plates are to be used for control purposes, they should be purchased from reliable manufacturers, or better, tested directly against pure sugar solutions by the observer.
In practice we have found quartz plates as a rule, true to their markings.
82. The Sugar Flask.—Sugar solutions are prepared for polarization in flasks graduated to hold fifty or one hundred cubic [Pg 99] centimeters. For scientific work a flask is marked to hold 100 grams of distilled water at 4°. The weights are all to be reduced to a vacuum standard. One flask having been marked in this way, others may be compared directly therewith by means of pure mercury. For this purpose the flasks must be perfectly dry and the mercury pure, leaving no stain on the sides of the flask. The glass must also be strong enough to undergo no change in shape from the weight of mercury used.
For sugar work the true 100 gram flask is not usually employed, but one graduated by weighing at 17°.5. These flasks are graduated by first weighing them perfectly dry, filling with distilled water and again weighing fifty and fifty-five, or 100 and 110 grams of water at the temperature named. Since the volume of water at 17°.5 is greater than at 4° the sugar flask in ordinary use has a greater volume by about 0.25 cubic centimeter than the true flask. The observer should always secure a statement from the dealer in respect of the volume of the flask used in testing the scale of the polariscope purchased. In the graduation of a flask in true cubic centimeters, when brass weights are used it will be necessary to correct the weight of each gram of water by adding to it one milligram, which is almost exactly the weight of the volume of air displaced by one gram of water in the circumstances named. If the flask be first counterbalanced and it be desired to mark it at 100 cubic centimeters the sum of the weights placed in the opposite pan should be 100 - 0.100 = 99.900 grams. While this is not a rigidly exact correction it will be sufficient for all practical purposes. A liter of dry air weighs 1.29366 grams; and 100 cubic centimeters of water would therefore displace 0.129 gram of air. But the brass weights also displace a volume of air which when deducted reduces the correction to be made for the water to nearly the one named. For convenience in inverting sugar solutions the flasks used in practical work are graduated at fifty and fifty-five and 100 and 110 cubic centimeters respectively.
83. Preparing Sugar Solutions for Polarization.—If sugar samples were always pure the percentage of sugar in a given solution could be directly determined by immediate polarization. Such cases, [Pg 100] however, are rarely met in practice. In the majority of cases the sample is not only to be brought into solution but is also to be decolorized and rendered limpid by some one of the methods to be described. A perfectly limpid liquid is of the highest importance to secure correct observations. With a cloudy solution the field of vision is obscured, the dividing line of the two halves, or the double line in the triple field, becomes blurred or invisible and the intensity of illumination is diminished. A colored liquid which is bright is far more easy to polarize than a colorless liquid which is turbid. In fact, it is only rarely in sugar work that samples will be found which require any special decolorizing treatment other than that which is received in applying the reagents which serve to make the solutions limpid. In the following paragraphs the approved methods of clarifying sugar solutions preparatory to observation in the polariscope will be described.
84. Alumina Cream.—The hydrate of alumina, commonly known as alumina cream, is always to be preferred as a clarifying agent in all cases where it can be successfully applied.[46] It is a substance that acts wholly in a mechanical way and therefore leaves the sugars in solution unchanged, carrying out only suspended matters. In the preparation of this reagent a solution of alum is treated with ammonia in slight excess, the aluminum hydroxid produced washed on a filter or by decantation until neutral in reaction. The hydroxid is suspended in pure water in proportions to produce a creamy liquid. Although apparently very bulky, the actual space occupied by the amount of dry hydroxid added in a few cubic centimeters is so small as to produce no disturbing effect of importance on the volume of the sugar solution. The cream thus prepared is shaken just before using and from one to five cubic centimeters of it, according to the degree of turbidity of the saccharine solution, are added before the volume in the flask is completed to the mark. After filling the flask to the mark the ball of the thumb is placed over the mouth and the contents well shaken and allowed to stand for a few moments before filtering.
The alumina cream is well suited to use with solutions of commercial sugars of not too low a grade and of most honeys and high grade sirups. [Pg 101] It is usually not powerful enough to clarify beet and cane juices, molasses and massecuites.
85. Basic Lead Acetate.—A solution of basic lead acetate is an invaluable aid to the sugar analyst in the preparation of samples for polarimetric observation. It acts as a clarifying agent by throwing out of solution certain organic compounds and by uniting with the organic acids in solution forms an additional quantity of precipitate, and these precipitates act also mechanically in removing suspended matters from solution. The action of this reagent is therefore much more vigorous than that of alumina cream. Coloring matters are often precipitated and removed by treatment with lead acetate. It happens therefore that there are few samples of saccharine bodies whose solutions cannot be sufficiently clarified by lead acetate to permit of polarimetric observation.
The reagent is most frequently employed of the following strength:[47] Boil for half an hour in one and a half liters of water 464 grams of lead acetate and 264 grams of litharge with frequent stirring. When cool, dilute with water to two liters, allow to stand until clear, and decant the solution. The specific gravity of this solution is about 1.267.
In a solution of basic lead acetate of unknown strength the percentage of lead acetate may be determined from its specific gravity by the following table:[48]
Percentage of Lead Acetate
Corresponding
to Different Specific Gravities at 15°.
| Specific gravity. |
Percentage of lead acetate. |
Specific gravity. |
Percentage of lead acetate. |
|---|---|---|---|
| 1.0127 | 2 | 1.2040 | 28 |
| 1.0255 | 4 | 1.2211 | 30 |
| 1.0386 | 6 | 1.2395 | 32 |
| 1.0520 | 8 | 1.2579 | 34 |
| 1.0654 | 10 | 1.2768 | 36 |
| 1.0796 | 12 | 1.2966 | 38 |
| 1.0939 | 14 | 1.3163 | 40 |
| 1.1084 | 16 | 1.3376 | 42 |
| 1.1234 | 18 | 1.3588 | 44 |
| 1.1384 | 20 | 1.3810 | 46 |
| 1.1544 | 22 | 1.4041 | 48 |
| 1.1704 | 24 | 1.4271 | 50 |
| 1.1869 | 26 |
[Pg 102] 86. Errors Due to use of Lead Solutions.—In the use of lead solutions there is danger of errors intruding into the results of the work. These errors are due to various sources. Lead subacetate solution, when used with low grade products, or sugar juices, or sirups from beets and canes, precipitates albuminous matters and also the organic acids present. The bulk occupied by these combined precipitates is often of considerable magnitude, so that on completing the volume in the flask the actual sugar solution present is less than indicated. The resulting condensation tends to give too high a polarimetric reading. With purer samples this error is of no consequence, but especially with low grade sirups and molasses it is a disturbing factor, which must be considered.
One of the best methods of correcting it has been proposed by Scheibler.[49] To 100 cubic centimeters of a solution of the sample, ten of lead solution are added, and after shaking and filtering the polarimetric reading is taken. Another quantity of 100 cubic centimeters of the solution with ten of lead is diluted to 220 cubic centimeters, shaken, filtered, and polarized. Double the second reading, subtract it from the first, multiply the difference by 2.2, and deduct the product from the first reading. The remainder is the correct polarization.
The process just described is for the usual work with beet juices and sirups. For cane juices measured by the graduated pipette, hereafter to be described, and for weighed samples of molasses and massecuites, the following method of calculation is pursued.[50] To the sample dissolved in water, add a measured portion of the lead subacetate solution, make its volume 100 cubic centimeters and observe the polarimetric reading. Prepare a second solution in the same way and make the volume double that of the first and again take the polarimetric reading. Multiply the second reading by two, subtract the product from the first reading and multiply the remainder by two, and subtract the product from the first reading.
| Example.— | First polarization | 30.0 | |
| Second polarization | 14.9 | ||
| Then 30 - (2 × 14.9 = 29.8) | = 0.2 | ||
| 0.2 × 2 | = 0.4 | ||
| and 30 - 0.4 | = 29.6 |
[Pg 103] The corrected reading therefore shows that the sample contained 29.6 per cent of sugar.
87. Error Due to Action of Lead Subacetate on Levulose.—In the use of lead subacetate solution not only is there danger of error due to the causes just described, but also to a more serious one, arising from the chemical interaction of the clarifying agent and levulose.[51]
Lead subacetate forms a chemical union with levulose and the resulting compound has a different rotatory power from the left-handed sugar in an uncombined state. By adding a sufficient quantity of subacetate solution, the left-handed rotation of levulose may be greatly diminished if not entirely destroyed. In this case the dextrose, which with levulose forms inverted sugar, serves to increase the apparent right rotation due to the sucrose in solution. The reading of the scale is therefore higher than would be given by the sucrose alone. If the lead subacetate could be added in just the proportion to make the invert sugar neutral to polarized light, its use would render the analysis more accurate; but such a case could only arise accidentally. To correct the error, after clarification, the compound of levulose and lead may be decomposed by the addition of acetic acid according to the method of Spencer. In this case the true content of sucrose can only be obtained by the method of inversion proposed by Clerget, which will be described in another paragraph.
88. Clarification with Mercuric Compounds.—Where the disturbing bodies in a solution are chiefly of an albuminoid nature, one of the best methods of securing clarification is by the use of a solution containing an acid mercuric compound.[52] In the case of milk this method is to be preferred to all others. Albuminoid bodies themselves, have the property of deflecting the plane of polarization, as a rule, to the left, and therefore, should be completely removed from solutions containing right-handed sugars such as lactose. For this purpose the mercuric compound is more efficient than any other. It is prepared and used as follows.[53] Dissolve mercury in double its weight of strong nitric acid and dilute the solution with an equal volume of water. One cubic centimeter of this solution is sufficient to clarify fifty times its volume of milk. [Pg 104]
89. Decolorization by Means of Bone-Black.—Where the means already described fail to make a solution sufficiently colorless to permit of the passage of a ray of polarized light, recourse should be had to a decolorizing agent. The most efficient of these is bone-black. For laboratory work it is finely ground and should be dry if added to an already measured solution. When moist it should be added to the flask before the volume is completed, and a correction made for the volume of the dry char employed. Bone-black has the power of absorbing a certain quantity of sugar, and for this reason as little of it should be employed as is sufficient to secure the end in view. If not more than one gram of the char be used for 100 cubic centimeters of solution, the error is not important commercially. The error may be avoided by placing the char on the filter and rejecting the first half of the filtered solution. The char becomes saturated with the first portion of the solution, and does not absorb any sugar from the second. This method, however, does not secure so complete a decolorization as is effected by adding the black directly to the solution and allowing to stand for some time with frequent shaking.
90. Remarks on Analytical Process.—Since large weights of sugar are taken for polarization, a balance which will weigh accurately to one milligram may be used. In commercial work the weighing is made in a counterpoised dish with a prominent lip, by means of which the sample can be directed into the mouth of the flask after partial solution. Where the air in the working room is still, an uncovered balance is most convenient. With a little practice the analyst will be able to dissolve and transfer the sample from the dish to the flask without danger of loss. The source of light used in polarizing should be in another room, and admitted by a circular opening in the partition. In a close polarizing room, which results from the darkening of the windows, the temperature will rapidly rise if a lamp be present, endangering notably the accuracy of the work, and also interfering with the comfort of the observer. The greatest neatness must be practiced in all stages of the work, and especially the trough of the polariscope must be kept from injury which may arise from the leaking of the observation tubes. [Pg 105] Dust and dirt of all kinds must be carefully excluded from the lenses, prisms, wedges and plates of the instrument.
91. Determination of Sucrose by Inversion.—In the foregoing paragraphs directions have been given for the estimation of sugar (sucrose) by its optical properties. It has been assumed so far, that no other disturbing bodies have been present, save those which could be removed by the clarifying agents described. The case is different when two or more sugars are present, each of which has a specific relation to polarized light. In such cases some method must be used for the optical determination of sucrose, which is independent of the influence of the other polarizing bodies, or else recourse must be had to other methods of analysis. The conversion of the sucrose present into invert sugar by the action of an acid or a ferment, affords an opportunity for the estimation of sucrose in mixed sugars, by purely optical methods. This process rests upon the principle that by the action of a dilute acid for a short time, or of a ferment for a long time, the sucrose is completely changed, while other sugars present are not sensibly affected. Neither of these assumptions is rigidly correct but each is practically applicable.
The sucrose by this process of hydrolysis is converted into an equal mixture of levulose and dextrose. The former, at room temperatures, has the higher specific rotating power, and the deflection of the plane of polarization in a solution of inverted sugar is therefore to the left. The levorotatory power of invert sugar varies with the temperature, and this arises from the optical properties of the levulose. The influence of temperature on the rotating power of other sugars, is not imperceptible in all cases, but in practice is negligible.
This method of analysis is invaluable in control work in factories, in the customs and in agricultural laboratories. Since the rotating power of levulose diminishes as the temperature rises, an accurate thermometric observation must accompany each polarimetric reading. At about 88° the rotatory powers of dextrose and levulose are equal, and a solution of pure invert sugar examined at that degree, is found to be neutral to polarized light.
92. Clerget’s Method of Inversion.—The classical method of [Pg 106] Clerget for the determination of cane sugar by double polarization before and after inversion, was first described in a memoir presented to the Society of Encouragement for National Industry on the 14th of October, 1846. The following description of the original method is taken from a reprint of the proceedings of that Society, dated Nov. 1846:
Clerget points out first the observation of Mitscherlich regarding the influence of temperature on the rotatory power of invert sugar, and calls attention to the detailed experiments he has made which resulted in the determination of the laws of the variation. From these studies he was able to construct a table of corrections, applicable in the analysis of all saccharine substances in which the cane sugar is polarized before and after inversion. The basis of the law rests upon the observation that a solution of pure sugar, polarizing 100° on the sugar scale, before inversion, will polarize 44° to the left after inversion at a temperature of zero. The quantity of sugar operated upon by Clerget amounted to 16.471 grams in 100 cubic centimeters of liquid. On the instrument employed by him this quantity of sugar in 100 cubic centimeters gave a reading of 100° to the right on the sugar scale when contained in a tube twenty centimeters in length. The process of inversion carried on by Clerget is as follows:
The sugar solution is placed in a flask, marked on the neck at 100 and 110 cubic centimeters; or if smaller quantities are used, in a flask marked on the neck at fifty and fifty-five cubic centimeters. The flask is filled with the sugar solution to the first mark and then a sufficient quantity of strong hydrochloric acid added to bring the volume of the liquid to the second mark. The mouth of the flask is then closed with the thumb and its contents thoroughly mixed by shaking. A thermometer is placed in the flask which is set in a water-bath in such a way that the water comes just above the level of the liquid in the neck of the flask. The water is heated in such a manner as to bring the temperature of the contents of the flask, as determined by the thermometer, exactly to 68° and at such a rate as to require fifteen minutes to reach this result. At the end of fifteen minutes the [Pg 107] temperature having reached 68° the flask is removed and placed at once in another water-bath at the temperature of the room, to which temperature the contents of the flask are cooled as rapidly as possible. To make the polarimetric observation a tube twenty-two centimeters in length is filled with the inverted sugar solution by means of a tubulure in its center, which serves not only the purpose of filling the tube but also afterwards to carry the thermometer, by means of which the temperature of observation can be taken. If the sugar solution be turbid, or contain any lead chlorid due to the previous use of basic lead acetate in clarification, it should be filtered before being introduced into the observation tube. This tube being one-tenth longer than the original compensates for the dilution caused by the addition of the hydrochloric acid in inversion.
When reading, the bulb of the thermometer should be withdrawn far enough to permit the free passage of the ray of light and the exact temperature of the solution noted.
The above outline of Clerget’s method of inversion is given in order that the analyst may compare it with any of the variations which he may find in other works. The chief points to which attention is called, are, first, the fact that only a little over sixteen grams of sugar are used for ten cubic centimeters of strong hydrochloric acid, and second, that the time of heating is exactly fifteen minutes, during which time the contents of the flask should be raised from room temperature to exactly 68°.
From the above it is seen that the process of Clerget, as originally described, can be applied directly to all instruments, using approximately sixteen grams of sugar in 100 cubic centimeters. Experience has also shown that even when larger quantities of sugar are employed, as for instance, approximately twenty-six grams, the inversion is effected with practical completeness in the same circumstances. It is advised, therefore, that in all analytical processes, in which cane sugar is to be determined by the process of inversion with an acid, the original directions of Clerget be followed as strictly as possible. Experience has shown that no one of the variations proposed for Clerget’s original method has any practical advantage and the analyst is especially cautioned against those methods [Pg 108] of inversion in which the temperature is continued at 68° for fifteen minutes or in which it is allowed to go above that degree.
93. Influence of Strength of Solution and Time of Heating on the Inversion of Sucrose.—As has been intimated, the strength of a sugar solution and the time of heating with hydrochloric acid are factors that must be considered in determining a formula for the calculation of sucrose by inversion. The Clerget formula holds good only for the conditions specified and these conditions must be rigidly adhered to in order to secure the proper results. This matter has been thoroughly studied by Bornträger, who also gives a nearly complete bibliography of the subject.[54] As a result of his investigations it seems well established that the original Clerget formula is practically correct for the conditions indicated, Bornträger modifying it only by substituting in the formula 143.66 for 144. This is so nearly the same as the Clerget factor that it is not advisable to substitute it therefor. If, however, the inverted sugar solution be diluted to double its volume before polarization the factor proposed by Landolt, viz., 142.4, gives more nearly accurate results. If the hydrochloric acid be neutralized before polarization by an alkaline body, the character of the salt which is formed also influences, to a greater or less extent, the specific rotatory power of the solution. Hydrochloric acid itself also influences the rotation to a certain degree.[55]
94. Calculation of Results.—The percentage of sucrose in a solution which has been polarized before and after inversion is calculated by an appropriate formula from the data obtained or is taken directly from tables. These tables are too long to insert here, and in point of fact the calculation can be made from the formula almost as quickly as the result can be taken from a table.
Two factors are commonly used in the calculations, one based on the supposition that a sugar solution polarizing 100° to the right will, after inversion, give a reading of 44° to the left, at zero temperature. In the second formula in common use the polarization to the left in the circumstances mentioned above is assumed to be 42.4, a number reached by Landolt after a long series of experiments.[56] The principle of the calculation of the percentage of sucrose is based upon [Pg 109] the original observation of Clerget to the effect that the algebraic difference of the two readings, divided by 144, less half of the temperature, will give the percentage of sucrose desired. The formula by which this is obtained is
| S = | a - b | . | |
| K - | t | ||
| 2 | |||
In this formula a is the polarization on the sugar scale before inversion, b the polarization after inversion, K the constant representing the algebraic difference of the two polarizations of pure sugar at 0° and t the temperature of the observation. To K may be assigned the values 144 or 142.4, the one in more common use. In case the polarization, after inversion, is to the left, which is more commonly the case, the sum of the two readings is taken for a - (-b) = a + b; when both polarizations are to the right or left the difference is taken. S is the percentage of sucrose desired.
| Example.— | Let the polarization before inversion be | +95 |
| and after inversion | -26 | |
| and the temperature | 20° |
| Then S = | 95 + 26 | = 121 ÷ 134 = 90.6. |
| 144 - 10 |
Substituting the value 142.4 for K, the result of the calculation is 91.4.
In high grade sugars, therefore, the difference in the results secured by taking the two values of K amounts to about 1 per cent of sucrose.
For a further discussion of the theory and practice of inversion the reader is referred to the articles of Herles, Herzfeld, and Wohl.[57]
95. Method Of Lindet.—Courtonne recommends the method of Lindet for securing the inversion instead of the method of Clerget.[58] Modified by Courtonne, the method is as follows:
Make two or three times the normal weight of sugar dissolved in water to a volume of 200 or 300 cubic centimeters, as the case may be. After thoroughly mixing proceed as follows:
First, to Obtain the Polarization Direct.—Place fifty or 100 cubic centimeters of the prepared solution in a flask marked at fifty and fifty-five or at 100 and 110 cubic centimeters, add a sufficient quantity of lead acetate to secure a complete clarification, make the [Pg 110] volume to fifty-five or 110 cubic centimeters, shake thoroughly, filter, and polarize in a 220 millimeter tube.
Second, to Obtain the Rotation after Inversion.—Place twenty cubic centimeters of the original solution, in a flask marked at fifty cubic centimeters, containing five grams of powdered zinc. The flask should be placed in boiling water. Add, little by little so as to avoid a too rapid evolution of hydrogen, ten cubic centimeters of hydrochloric acid made of equal parts of the strongest acid and water. After the operation is terminated, cool to the temperature of the room, make the volume to fifty cubic centimeters, polarize, and determine the rotation. The volume occupied by the zinc which is not dissolved, will be about one-half cubic centimeter, hence the deviation should be multiplied by the factor 2.475 in order to get the true deviation which would have been produced by the pure liquor. We have then:
The amount of sucrose, therefore, would be calculated by the formula of Creydt,[59]
| X = | C - 0.493A | ; |
| 0.827 |
for raffinose the formula would be
| Y = | A - S | ; |
| 1.57 |
in which S is the deviation due to the sucrose present. The solutions inverted in the manner described are absolutely colorless. There is no need of employing bone-black to secure the saccharimetric reading nor does it present any uncertainty. It is thought by Courtonne that this method will soon take the place of the method of Clerget on account of the advantages above mentioned. The method will be somewhat improved by adopting the following suggestions:
1. Instead of allowing any arbitrary number for the volume of the undissolved zinc, decant the liquid, after inversion, into another flask and wash repeatedly with hot water until all trace of sugar is removed from the flask in which the inversion took place.
2. Instead of polarizing in a 200 millimeter tube make the observation in a 500 millimeter tube, which will permit of the reading being made without any correction whatever. [Pg 111]
96. Inversion by Means of Invertase.—Instead of using acids for the inversion of cane sugar the hydrolysis can be easily effected by means of a ferment derived from yeast. A complete history of the literature and characteristics of this ferment, together with a study of its properties and the various methods of preparing it, has been given by O’Sullivan and Tompson.[60] In the preparation of invertase, the method found most effective is the following:
The yeast is allowed to liquify for at least a month in a fairly warm room without stirring. At the end of this time the surface is removed and any supernatant liquid poured away. The lower sedimentary part is thrown on a quick-acting filter and allowed to drain for two days. To the filtrate, alcohol of specific gravity 0.87 is gradually added to the extent of one and a half times its volume, with continued and vigorous stirring. The process of adding the alcohol and stirring should require about half an hour, after which the mixture is allowed to stand for twenty-four hours to allow the precipitated invertase to settle. The supernatant liquid is poured away and the precipitate washed several times on successive days by decantation with alcohol of 0.92 specific gravity. When the washings become nearly colorless the precipitate is thrown on a filter, allowed to drain, and immediately removed and mixed with a large bulk of alcohol of 0.92 specific gravity. The precipitate is again collected, mixed thoroughly with its own bulk of water, and some alcohol of 0.97 specific gravity, allowed to stand for a few hours and thrown on a filter. The filtrate contains the invertase.
97. Determination of Activity of Invertase.—The activity of a solution of invertase, prepared as above, is measured by the number of minutes required for it to reduce to zero the optical power of a solution of 100 times its weight of cane sugar at a temperature of 15°.5. In order to facilitate the action of the invertase, a trace of sulfuric acid is added to the solution. The manipulation is as follows:
Fifty grams of sucrose are dissolved in water and made to a volume of nearly a quarter of a liter and placed in a bath maintained at 15°.5. Half a gram of the invertase is added, the time noted, the solution immediately made up to a quarter of a liter and well shaken. The [Pg 112] contents of the flask are poured rapidly into five beakers; the actual quantity in each beaker is not necessarily the same. To each of these beakers, in succession, are added the following amounts of decinormal sulfuric acid, viz., one-tenth, three-tenths, six-tenths, one, and one and four-tenths cubic centimeters. After an hour a small quantity of the solution is taken from beaker No. 3 and the reaction of the invertase stopped by adding a few drops of strong potassium hydroxid and the time of adding this reagent noted. This solution is then read in the polariscope and the percentage of sugar inverted is calculated from the formula C₁₂H₂₂O₁₁ + H₂O = C₆H₁₂O₆ + C₆H₁₂O₆.
The calculation of the amount of cane sugar inverted is based on the formula,
(38.4 - d) ÷ 0.518 = p.
In this formula d equals the divisions of the sugar scale read on the polariscope; p the percentage of cane sugar inverted; 38.4 the reading on the sugar scale of the original sugar solution and 51.8 the total number of divisions of the cane sugar scale that the polariscope reading would fall through if all the sugar were inverted. The observation tubes used in the polarization are only 100 millimeters in length. After stopping the action of the invertase with potassium hydroxid the solution is allowed to stand for some time before polarization inasmuch as the dextrose formed appears to assume the state of birotation and some time is required for it to reach its normal rotatory power. If the invertase be used in the alcoholic solution a sufficient quantity should be added to be equivalent to 0.01 of the sucrose present. The time which the contents of beaker No. 3 will take to reach optical activity is calculated in a manner described by O’Sullivan and Tompson, but too long to be inserted here.[61] The five beakers mentioned above are examined in succession and the amount of sulfuric acid best suited to the maximum inversion thus determined. This quantity is then used in subsequent hydrolyses with the given sample of invertase.
The action of invertase on sucrose is very rapid at the first and becomes very much slower towards the end. At a temperature of 15°.5 it is advisable to let the solution stand for forty-eight hours in order to be sure that complete inversion has taken place. For this reason the [Pg 113] method by inversion by means of invertase is one of no great practical importance, but it may often be useful to the analyst when the employment of an acid is inadmissible.
98. Inversion by Yeast.—Owing to the difficulty of preparing invertase, O’Sullivan and Thompson[62] propose to use yeast as the hydrolytic agent, as first suggested by Kjeldahl. It is shown that in the use of yeast it is not necessary to employ thymol or any other antiseptic. The method of procedure is as follows: The cane sugar solution of usual strength should not be alkaline, but, if possible, should be exactly neutral. If there be any ferment suspected, the temperature should be momentarily raised to 80° to destroy its activity. The polariscopic reading of the solution is then taken at 15°.5 and the amount of copper reduced by the solution should also be determined.
Fifty cubic centimeters of the solution are poured into a beaker and raised to a temperature of 55° in a constant temperature bath. Some brewers yeast amounting to about one-tenth of the total amount of sugar to be inverted, pressed in a towel, is thrown into the hot solution and the whole stirred until mixture is complete. The solution is left for four hours in the water-bath, at the end of this time it is cooled to 15°.5, a little freshly precipitated aluminum hydroxid added, and the volume made to 100 cubic centimeters. A portion of this solution is filtered and its polariscopic reading observed. The solution is then left till the next day, when another polariscopic reading is taken in order to prove that inversion is complete. The copper reducing power is also determined. The method of calculating the results is the same as when invertase is used. The following formulas are employed.
a = the number of divisions indicated by the polariscopic reading for a 200 millimeter tube:
aʹ = the same number after inversion:
m = the number of the divisions of the polariscopic scale which 200 millimeters of the sugar solution containing one gram of cane sugar per 100, alter at 15°.5 on being inverted: In the case of the ventzke polarimeter scale, one gram of cane sugar in 100 cubic centimeters, [Pg 114] indicates +3.84 divisions and after inversion it gives -1.34 div. In experiments of this kind, therefore, m = 5.18.
P = the weight of cane sugar present in 100 cubic centimeters of the original solution:
The formula employed then is
| P = | a - 2aʹ | . |
| m |
For the copper reduction data the following are used:
G = the weight of 100 cubic centimeters of the original solution:
Gʹ; = the same for the inverted solution: Allowance must be made here both for the dilution and for the 5 per cent increase of the inverted sugar, but the latter number is so small that it need not be calculated accurately.
w = the weight of the original solution used for the estimation:
wʹ = the same factor for the inverted solution:
k = the weight of cupric oxid reduced by w:
kʹ = the same factor for wʹ:
p = the weight of cane sugar present in 100 cubic centimeters of the original solution: The formula to be employed then is
| p = 0.4308
|
Gʹ kʹ | - | G k | |
| wʹ | w |
This method has been applied to the estimation of cane sugar in molasses, apple juices and other substances. It is recommended by the authors as a simple and accurate means of estimating sucrose in all solutions containing it. The methods of making the copper reductions will be given hereafter.
99. Application of the Process.—In practice the process of inversion is used chiefly in the analysis of molasses and low grade massecuites. In approximately pure sugars the direct polarization is sufficiently accurate for all practical purposes. In molasses resulting from the manufacture of beet sugar are often found considerable quantities of raffinose, and the inversion process has been adapted to that character of samples. In molasses, in sugar cane factories, the disturbing factors are chiefly invert sugars and gums. The processes used for molasses will be given in another paragraph. In certain determinations of lactose the process of inversion is also practiced, but in this case the lactose is converted into dextrose and galactose, [Pg 115] and the factors of calculation are altogether different. The process has also been adapted by McElroy and Bigelow to the determination of sucrose in presence of lactose, and this method will be described further on. In general the process of inversion is applicable to the determination of sucrose in all mixtures of other optically active bodies, which are not affected by the methods of inversion employed.
100. Determination of Sucrose and Raffinose.—Raffinose is a sugar which often occurs in beets, and is found chiefly in the molasses after the chief part of the sucrose has been removed by crystallization. It is also found in many seeds, notably in those of the cotton plant. In a pure solution of sucrose and raffinose, both sugars may be determined by the inversion method of Creydt.[63] The inversion is effected by means of hydrochloric acid in the manner described by Clerget. The following formulas are calculated for a temperature of observation of 20°, and the readings should be made as near that temperature as possible.
| (1)S = | C - 0.493A |
| 0.827 |
| (2) R = | A - S | = 1.017A - | 6 |
| 1.57 | 1.298 |
In these formulas S and R are the respective per cents of sucrose and raffinose desired, A the polarization in sugar degrees before inversion, B the polarization after inversion read at 20°, and C is the algebraic difference between A and B. It must be understood that these formulas are applicable only to a solution containing no other optically active substances, save sucrose and raffinose.
101. Specific Rotatory Power.—In order to compare among themselves the rotations produced on a plane of polarized light by different optically active bodies in solution, it is convenient to refer them all to an assumed standard. The degree of rotation which the body would show in this condition, is found by calculation, since, in reality, the conditions assumed are never found in practice. In the case of sugars and other optically active bodies, the standard of comparison is called the specific rotatory power. This factor in any [Pg 116] given case, is the angular rotation which would be produced by any given substance in a pure anhydrous state if it were one decimeter in length and of a specific gravity equal to water. These are conditions which evidently do not exist in the case of sugars, since crystalline sugar particles have no polarizing power, and it would be impossible to pass a ray of light through an amorphous sugar column of the length specified. The specific rotatory power is therefore to be regarded as a purely theoretical factor, calculated from the actual data obtained by the examination of the solution of any given substance. If the length of the observation tube in decimeters be represented by l, the percentage of the polarizing body in 100 grams by p, and the specific gravity of the solution by d, and the observed angle of rotation by a, then the factor is calculated from the formula:
| [a]Dj = | a. 100 | . |
| p. d. l. |
The symbols Dj refer to the character of light employed, D indicating the monochromatic sodium flame, and j the transition tint from white light.
If the weight of the polarizing body c be given or known for 100 cubic centimeters of the solution the formula becomes
| [a]Dj = | a. 100 | . |
| c. l. |
The latter formula is the one easier of application since it is only necessary in applying it to dissolve a given weight of the active body in an appropriate solvent and to complete the volume of the solution exactly to 100 cubic centimeters. It is therefore unnecessary in this case to determine the specific gravity.
102. Formulas for Calculating Specific Rotatory Power.—In order to determine the specific rotatory power (gyrodynat[64]) of a given substance it is necessary to know the specific gravity and percentage composition or concentration of its solution, and to examine it with monochromatic polarized light in an instrument by which the angular rotation can be measured. The gyrodynat of any body changes with its degree of concentration, in some cases with the temperature, and always with the color of the light. With the red rays the gyrodynat is least [Pg 117] and itprogressively increases as the violet end of the spectrum is approached. In practice the yellow ray of the spectrum has been found most convenient for use, and in the case of sugars the gyrodynat is always expressed either in terms of this ray or if made with color compensating instruments in terms of the sensitive or transition tint. In the one case the symbol used is (a)D and in the other (a)j. From this statement it follows that (a)D is always numerically less than (a)j. Unless otherwise specified the gyrodynat of a body is to be considered as determined by yellow monochromatic light, and therefore corresponds to aD.[65]
103. Variations in Specific Rotatory Power.—The gyrodynat of any optically active body varies with the nature of the solvent, the strength of the solution, and the temperature.[66]
Since water is the only solvent of importance in determining the gyrodynat of sugars it will not be necessary here to discuss the influence of the nature of the solvent. In respect of the strength of the solution it has been established that in the case of cane sugar the gyrodynat decreases while with dextrose it increases with the degree of concentration. The influence of temperature on the gyrodynat of common sugars is not of great importance save in the case of levulose, where it is the most important factor, the gyrodynat rapidly increasing as the temperature falls. It is of course understood that the above remarks do not apply to the increase or decrease in the volume of a solution at changed temperatures. This influence of temperature is universally proportional to the change of volume in all cases, and this volumetric change is completely eliminated when the polarizations are made at the temperatures at which the solutions are completed to standard volumes.
104. Gyrodynatic Data for Common Sugars.—In the case of cane sugar the gyrodynat for twenty-five grams of sugar in 100 grams of solution at 20° is [a]D = 66°.37. This is about the degree of concentration of the solutions employed in the shadow lamplight polariscopes. For seventeen grams of sugar in 100 grams of solution the number is [a]D = 66°.49. This is approximately the degree of concentration for the laurent instrument. [Pg 118]
For any degree of concentration according to Tollens the gyrodynat may be computed by the following formula: [a]D = 66°.386 + 0.015035p - 0.0003986p², in which p is the number of grams of sugar in 100 grams of the solution.[67] In the table constructed by Schmitt the data obtained are as follows:
| In 100 parts by weight of solution. |
Specific gravity |
Concentration | Rotation a for 100 mm. |
[a]D. | |
|---|---|---|---|---|---|
| Sugar p. | Water q. | at 20° C.d. | c = pd. | at 20° C. | |
| 64.9775 | 35.0225 | 1.31650 | 85.5432 | 56°.134 | 65°.620 |
| 54.9643 | 45.0357 | 1.25732 | 69.1076 | 45°.533 | 65°.919 |
| 39.9777 | 60.0223 | 1.17664 | 47.0392 | 31°.174 | 66°.272 |
| 25.0019 | 74.9981 | 1.10367 | 27.5938 | 18°.335 | 66°.441 |
| 16.9926 | 83.0074 | 1.06777 | 18.1442 | 12°.064 | 66°.488 |
| 9.9997 | 90.0003 | 1.03820 | 10.3817 | 6°.912 | 66°.574 |
| 4.9975 | 95.0025 | 1.01787 | 5.0868 | 3°.388 | 66°.609 |
| 1.9986 | 98.0014 | 1.00607 | 2.0107 | 1°.343 | 66°.802 |
105. Bi-Rotation.—Some sugars in fresh solution show a gyrodynat much higher than the normal, sometimes lower. The former phenomenon is called bi- the latter semi-rotation. Dextrose shows birotation in a marked degree, also maltose and lactose. After standing for a few hours, or immediately on boiling, solutions of these sugars assume their normal state of rotation. The addition of a small quantity of ammonia also causes the birotation to disappear.[68] This phenomenon is doubtless due to a certain molecular taxis, which remains after solution is apparently complete. The groups of molecules thus held in place have a certain rotatory power of their own and this is superadded to that of the normal solution. After a time, under the stress of the action of the solvent, these groups are broken up and the solution then assumes its normal condition.
106. Gyrodynat of Dextrose.—The gyrodynat of dextrose, as has already been mentioned, increases with the degree of concentration, thus showing a property directly opposite that of sucrose.
The general formula for the anhydrous sugar is [a]D = 52.°718 + 0.017087p + 0.0004271p². In this formula p represents the grams of dextrose in 100 grams of the solution. In a ten per cent solution the gyrodynat of dextrose is therefore nearly exactly [a]D20° = 53°. As calculated by Tollens the gyrodynats corresponding to several degrees of concentration are shown in the following table: [Pg 119]
| p = grams in 100 grams of solution. |
[a]D20°
calculated for anhydrous dextrose. |
|
|---|---|---|
| 7.6819 | 52°.89 | |
| 9.2994 | 52°.94 | |
| 9.3712 | 52°.94 | |
| 10.0614 | 52°.96 | |
| 10.6279 | 52°.98 | |
| 12.9508 | 53°.05 | |
| 18.6211 | 53°.25 | |
| 31.6139 | 53°.83 | |
| 40.7432 | 54°.34 | |
| 43.9883 | 54°.54 | |
| 53.0231 | 55°.17 | |
| 82.6111 | 57°.80 |
107. Gyrodynats of Other Sugars.—Of the other sugars it will be sufficient to mention only levulose, maltose, lactose, and raffinose. For complete tables of gyrodynatic powers the standard books on carbohydrates may be consulted.[69]
The gyrodynat of levulose is not definitely established. At 14° the number is nearly expressed by [a]D14° = -93°.7.
Invert sugar, which should consist of exactly equal molecules of dextrose and levulose, has a gyrodynat expressed by the formula [a]D0° = -27°.9, with a concentration equivalent to 17.21 grams of sugar in 100 cubic centimeters. The gyrodynat decreases with increase of temperature, according to the formula [a]Dt° = - (27°.9 - 0.32t°). According to this formula the solution is neutral to polarized light at 87°.2, and this corresponds closely to the data of experiment.
Maltose, in a ten per cent solution at 20°, shows a gyrodynat of [a]D20° = 138°.3.
The general formula for other degrees of concentration is [a]D = 140°.375 - 0.01837p - 0.095t, in which p represents the number of grams in 100 grams of the solution and t the temperature of observation.
In the case of lactose [a]D = 52°.53, and this number does not appear to be greatly influenced by the degree of concentration; but is somewhat diminished by a rising temperature.
The gyrodynat of raffinose in a ten per cent solution is [a]D = 104°.5. [Pg 120]
108. General Principles.—The methods for the chemical estimation of sugars in common use depend on the reducing actions exerted on certain metallic salts, whereby the metal itself or some oxid thereof, is obtained. The reaction is either volumetric or the resulting oxid or metal may be weighed. The common method is, therefore, resolved into two distinct processes, and each of these is carried out in several ways. Not all sugars have the faculty of exerting a reducing action on highly oxidized metallic salts and the most common of them all, viz., sucrose is practically without action. This sugar, however, by simple hydrolysis, becomes reducing, but the two components into which it is resolved by hydrolytic action do not reduce metallic salts in the same proportion. Moreover, in all cases the reducing power of a sugar solution is largely dependent on its degree of concentration, and this factor must always be taken into consideration. Salts of copper and mercury are most usually selected to measure the reducing power of a sugar and in point of fact copper salts are almost universally used. Copper sulfate and carbonate are the salts usually employed, and of these the sulfate far more frequently, but after conversion into tartrate. Practically, therefore, the study of the reducing action of sugar as an analytical method will be confined almost exclusively to the determination of its action on copper tartrate.
Direct gravimetric methods are also practiced to a limited extent in the determination of sugars as in the use of the formation of sucrates of the alkaline earths and of the combinations which certain sugars form with phenylhydrazin. Within a few years this last named reaction has assumed a marked degree of importance as an analytical method. The most practical treatment of this section, therefore, for the limited space which can be given it, will be the study of the reducing action of sugars, both from a volumetric and gravimetric point of view, followed by a description of the best approved methods of the direct precipitation of sugars by such reagents as barium hydroxid and phenylhydrazin. [Pg 121]
109. Classification.—Among the volumetric methods will be given those which are in common use or such as have been approved by the practice of analysts. Since the use of mercuric salts is now practiced to a limited extent, only a brief study of that process will be attempted. With the copper methods a somewhat extended description will be given of those depending on the use of copper sulfate, and a briefer account of the copper carbonate process.
In the copper sulfate method two distinct divisions must be noted, viz., first an indirect process depending first upon the reduction of the copper to a suboxid, the subsequent action of this body on iron salts, measured finally by titration with potassium permanganate; and second, a direct process determined either by the disappearance of the blue color from the copper solution, or by the absence of copper from a drop of the solution withdrawn and tested with potassium ferrocyanid. This last mentioned reaction is one which is found in common use. The volumetric methods are not, as a rule, as accurate as the gravimetric, depending on weighing the resultant metal, but they are far more rapid and well suited to technical control determinations.
110. Reduction of Mercuric Salts.—The method of determining sugar by its action on mercuric salts, is due to Knapp.[70] The method is based on the observation that dextrose and other allied sugars, will reduce an alkaline solution of mercuric cyanid, and that the mercury will appear in a metallic state.
The mercuric liquor is prepared by adding to a solution of ten grams of mercuric cyanid, 100 cubic centimeters of a solution of caustic soda of 1.145 specific gravity, and making the volume to one liter with water. The solution of sugar to be titrated, should be as nearly as possible of one per cent strength.
To 100 cubic centimeters of the boiling solution, the sugar solution is added in small portions from a burette and in such a way as to keep the whole mass in gentle ebullition.
To determine when all the mercuric salt has been decomposed, a drop of the clear boiling liquid is removed and brought into contact with a drop of stannous chlorid solution on a white surface. A brownish black [Pg 122] coloration or precipitate will indicate that the mercury is not all precipitated. Fresh portions of the sugar must then be added, until no further indication of the presence of mercury is noted. The approximate quantity of sugar solution required to precipitate the mercury having thus been determined, the process is repeated by adding rapidly, nearly the quantity of sugar solution required, and then only a few drops at a time, until the reduction is complete.
One hundred cubic centimeters of the mercuric cyanid solution prepared as directed above, will be completely reduced by
| 202 | milligrams | of | dextrose, |
| 200 | ” | ” | invert sugar, |
| 198 | ” | ” | levulose, |
| 308 | ” | ” | maltose, |
| 311 | ” | ” | lactose. |
By reason of the unpleasant odor of the boiling mercuric cyanid when in presence of a reducing agent, the process should be conducted in a well ventilated fume chamber. With a little practice the process is capable of rapid execution, and gives reasonably accurate results.
111. Sachsse’s Solution.—The solution of mercuric salts proposed by Sachsse, is made by dissolving eighteen grams of mercuric iodid in twenty-five cubic centimeters of an aqueous solution of potassium iodid. To this solution are added 200 cubic centimeters of potash lye, containing eighty grams of caustic potash. After mixing the solution, the volume is completed to one liter. The sugar solutions used to reduce this mixture, should be more dilute than those employed with the mercuric cyanid, and should not be over one-half per cent in strength. The end of the reduction is determined as already described. After a preliminary trial, nearly all the sugar necessary to complete reduction, should be added at once, and the end of the reduction then determined by the addition of successive small quantities. One hundred cubic centimeters of the mercuric iodid solution prepared as directed above, require the following quantities of sugar to effect a complete reduction:
| 325 | milligrams | of | dextrose, |
| 269 | ” | ” | invert sugar, |
| 213 | ” | ” | levulose, |
| 491 | ” | ” | maltose, |
| 387 | ” | ” | lactose. |
[Pg 123] By reason of the great difference between the reducing power of dextrose and levulose in this solution, it has been used in combination with the copper reduction method, to be described, to determine the relative proportion of dextrose and levulose in a mixture.[71]
It is now known that copper solutions require slightly different quantities of dextrose, levulose, or invert sugar to effect complete reduction, but the variations are not great and in the calculation above mentioned, it may be assumed that these differences do not exist.
Instead of using stannous chlorid as an indicator, the end of the reaction may be determined as follows: A disk of filtering paper is placed over a small beaker containing some ammonium sulfid. A drop of the clear hot solution is placed on this disk, and if salts of mercury be still present a dark stain will be produced; or a drop of the ammonium sulfid may be brought near the moist spot formed by the drop of mercury salt. An alkaline solution of zinc oxid may also be used.
The methods depending on the use of mercuric salts have, of late, been supplanted by better processes, and space will not be given here to their further discussion.
112. The Volumetric Copper Methods.—The general principle on which these methods depend, is found in the fact that certain sugars, notably, dextrose, (glucose), levulose, (fructose), maltose and lactose, have the property of reducing an alkaline solution of copper to a lower state of combination, in which the copper is separated as cuprous oxid. The end of the reaction is either determined by the disappearance of the blue color of the solution, or by the reaction produced by a drop of the hot filtered solution, when placed in contact with a drop of potassium ferrocyanid acidified with acetic.
The copper salt which is found to give the most delicate and reliable reaction, is the tartrate. The number of volumetric processes proposed and which are in use, is very great, and an attempt even to enumerate all of these can not be made in this volume. A few of the most reliable and best attested methods will be given, representing if possible, the best practice in this and other countries. The rate of reduction of the [Pg 124] copper salt to suboxid, is influenced by the rate of mixing with the sugar solutions, the temperature, the composition of the copper solution and the strength of the sugar solution.
The degree of reduction is also modified by the rate at which the sugar solution is added, and by the degree and duration of heating, and all these variables together, make the volumetric methods somewhat difficult and their data, to a certain extent, discordant. By reason, however, of the ease with which they are applied and the speed of their execution, they are invaluable for approximately correct work and for use in technical control.
113. Historical.—It is not the purpose in this paragraph to trace the development of the copper reduction method for the determination of reducing sugars, but only to refer to the beginning of the exact analytical application of it.
Peligot, as early as 1844, made a report to the Society for the Encouragement of National Industry on methods proposed by Barreswil and Fromherz for the quantitive estimation of sugar by means of copper solution.[72] These methods were based on the property of certain sugars to reduce alkaline copper solution to a state of cuprous oxid first announced by Trommer.[73] This was followed by a paper by Falck on the quantitive determination of sugar in urine.[74]
In 1848 the methods, which have been proposed, were critically examined by Fehling, and from the date of his paper the determination of sugar by the copper method may be regarded as resting on a scientific basis.[75]
Since the date mentioned the principal improvements in the process have been in changing the composition of the copper solution in order to render it more stable, which has been accomplished by varying the proportions of copper sulfate, alkali and tartaric acid. For the better keeping of the solution the method of preserving the copper sulfate and the alkaline tartrates in separate flasks and only mixing them at the time of use has been found very efficacious.[76] For testing for the end of the reaction by means of an acetic acid solution of potassium ferrocyanid the filtering tube suggested by the author, the use of which will be described further on, has proved quite [Pg 125] useful. Pavy has suggested that by the addition of ammonia to the copper solution the precipitated suboxid may be kept in solution and the end of the reaction thus easily distinguished by the disappearance of the blue color.[77] Allen has improved on this method by covering the hot mixture with a layer of paraffin oil whereby any oxidation of the suboxid is prevented.[78]
The introduction and development of the gravimetric process depending on securing the reduced copper oxid in a metallic state as developed by Allihn, Soxhlet, and others, completes the resumé of this brief sketch of the rise and development of the process.
114. Action of Alkaline Copper Solution on Dextrose.—The action to which dextrose and other reducing sugars are subjected in the presence of a hot alkaline copper solution is two-fold in its nature. In the first place there is an oxidation of the sugar which is transformed into tartronic, formic and oxalic acids, the two latter in very small quantities. At the same time another part of the sugar is attacked directly by the alkali and changed to complex products among which have been detected lactic, oxyphenic and oxalic acids, also two bodies isomeric with dioxyphenolpropionic acid. When the sugar is in large excess melassic and glucic acids have also been detected. The glucic acid may be regarded as being formed by simple dehydration but becomes at once resolved into pyrocatechin and gluconic acid according to the reaction C₁₂H₁₈O₉ = C₆H₆O₂ + C₅H₁₂O₇. The gluconic acid also is decomposed and gives birth to lactic and glyceric acids according to the formula C₆H₁₂O₇ = C₃H₆O₃ + C₃H₆O₄. The glyceric acid also in the presence of a base is changed into lactic and oxalic acids. Between lactic acid and pyrocatechin, existing in a free state, there is produced a double reciprocal etherification in virtue of which there arise two ethers isomeric with hydrocaffeic acid, C₉H₁₀O₄. One of these bodies is an acid and corresponds to the constitution
and the other is of an alcoholic nature corresponding to the formula [Pg 126]
Of all these products only oxyphenic and lactic acids and their ethers and oxalic acid remain unchanged and they can be isolated. All the others are transformed in an acid state and they can only be detected by operating in the presence of metallic oxids capable of precipitating them at the time of their formation.[79]
115. Fehling’s Solution.—The copper solution which has been most used in the determination of reducing sugars is the one proposed by Fehling as a working modification of the original reagent used by Trommer.[80]
Following is the formula for the preparation of the fehling solution:
| Pure crystallized copper sulfate CuSO₄.5H₂O, | 34.64 | grams: |
| Potassium tartrate, | 150.00 | ” |
| Sodium hydroxid, | 90.00 | ” |
The copper sulfate is dissolved in water and the potassium tartrate in the aqueous solution of the sodium hydroxid which should have a volume of about 700 cubic centimeters. The two solutions are mixed and the volume completed to a liter. Each cubic centimeter of this solution will be reduced by five milligrams of dextrose, equivalent to four and a half milligrams of sucrose.
The reaction which takes place is represented by the following molecular proportions:
| C₆H₁₂O₆ | = | 10CuSO₄.5H₂O |
| Dextrose. | Copper sulfate. | |
| 180 | 2494 |
Fehling’s solution is delicate in its reactions but does not keep well, depositing cuprous oxid on standing especially in a warm place exposed to light. The fehling liquor was soon modified in its constitution by substituting 173 grams of the double sodium and potassium tartrate for the neutral potassium tartrate first used, and, in fact, the original fehling reagent contained forty grams of copper sulfate instead of the [Pg 127] quantity mentioned above. Other proportions of the ingredients are also given by many authors as fehling solution.
116. Comparison of Copper Solutions for Oxidizing Sugars.—For the convenience of analysts there is given below a tabular comparison of the different forms of fehling liquor which have been proposed for oxidizing sugars. The table is based on a similar one prepared by Tollens and Rodewald, amended and completed by Horton.[81] The solutions are arranged alphabetically according to authors’ names:
1. Allihn:
34.6 grams copper sulfate, solution made up to half a liter; 173 grams potassium-sodium tartrate; 125 grams potassium hydroxid (equivalent to 89.2 grams sodium hydroxid) solution made up to half a liter.
2. A. H. Allen:
34.64 grams copper sulfate, solution made up to 500 cubic centimeters; 180 grams potassium-sodium tartrate; 70 grams sodium hydroxid (not less than 97° NaOH), solution made up to half a liter.
3. Bödeker:
34.65 grams copper sulfate; 173 grams potassium-sodium tartrate; 480 cubic centimeters sodium hydroxid solution, 1.14 specific gravity; 67.3 grams sodium hydroxid; fill to one liter; 0.180 gram grape sugar reduces according to Bödeker, 36.1 cubic centimeters of the copper solution = 0.397 gram copper oxid. The same quantity of milk sugar reduces, however, only twenty-seven cubic centimeters copper solution = 0.298 copper oxid.
4. Boussingault:
40 grams copper sulfate; 160 grams potassium tartrate; 130 grams sodium hydroxid.
5. Dietzsch:
34.65 grams copper sulfate; 150 grams potassium-sodium tartrate; 250 grams sodium hydroxid solution, 1.20 specific gravity; 150 grams glycerol.
6. Fleischer:
69.278 grams copper sulfate dissolved in about half a liter of water, add to this 200 grams tartaric acid; fill to one liter with concentrated sodium hydroxid solution; twenty cubic centimeters copper solution = forty cubic centimeters sugar solution, that contain in every cubic centimeter five milligrams grape sugar.
7. Fehling:
40 grams copper sulfate; 160 grams di-potassium tartrate = 600-700 cubic centimeters sodium hydroxid solution, 1.12 specific gravity, or from 54.6 to 63.7 grams sodium hydroxid, fill to 1154.4 cubic [Pg 128] centimeters.
8. Gorup-Besanez:
34.65 grams copper sulfate; 173 grams potassium-sodium tartrate; 480 cubic centimeters sodium hydroxid solution, 1.14 specific gravity; equal 67.3 sodium hydroxid. Fill to one liter.
9. Grimaux:
40 grams copper sulfate; 160 grams potassium-sodium tartrate; 600-700 cubic centimeters sodium hydroxid solution, 1.20 specific gravity, equal to 92.5-107.9 grams sodium hydroxid. Fill to 1154.4 cubic centimeters. Ten cubic centimeters of this solution are completely decolorized by 0.050 gram glucose.
10. Holdefleis:
34.632 grams copper sulfate in one liter of water; 125 grams potassium hydroxid, equivalent to 89.2 grams sodium hydroxid; 173 grams potassium-sodium tartrate. Fill to one liter.
11. Hoppe-Seyler:
34.65 grams copper sulfate; 173 grams potassium-sodium tartrate; 600-700 cubic centimeters sodium hydroxid solution, 1.12 specific gravity; equal to 63.0-73.5 grams potassium hydroxid. Fill to one liter. One cubic centimeter is reduced by exactly 0.005 gram grape sugar.
12. Krocker:
6.28 grams copper sulfate; 34.6 grams potassium-sodium tartrate; 100 cubic centimeters sodium hydroxid solution, 1.14 specific gravity. Fill to 200 cubic centimeters. In 100 cubic centimeters of this solution is contained 0.314 gram copper sulfate, which is reduced by 0.050 grape sugar.
13. Liebermann:
4 grams copper sulfate; 20 grams potassium-sodium tartrate; 70 grams sodium hydroxid solution, 1.12 specific gravity. Fill to 115.5 cubic centimeters.
14. Löwe:
15 grams copper sulfate; 60 grams glycerol; 80 cubic centimeters sodium hydroxid, 1.34 specific gravity; 160 cubic centimeters water. Fill to half a liter.
15. Mohr:
34.64 copper sulfate; 150 grams di-potassium tartrate; 600-700 cubic centimeters sodium hydroxid solution, 1.12 specific gravity, equal to 70.5-82.3 grams sodium hydroxid. Fill to one liter.
16. Märcker:
35 grams copper sulfate, solution made up to one liter: 175 grams potassium-sodium tartrate; 125 grams potassium hydroxid, equivalent to 89.2 grams sodium hydroxid, solution made up to one liter.
17. Maumenè:
375 grams copper sulfate; 188 grams potassium-sodium tartrate; [Pg 129]
166 grams potassium hydroxid. Fill to nine liters.
18. Monier:
40 grams copper sulfate; 3 grams stannic chlorid; 80 grams cream of tartar; 130 grams sodium hydroxid. Fill to one liter.
19. Neubauer and Vogel:
34.639 grams copper sulfate; 173 grams potassium-sodium tartrate; 500-600 grams sodium hydroxid solution, 1.12 specific gravity. Fill to one liter.
20. Pasteur:
40 grams copper sulfate; 105 grams tartaric acid; 80 grams potassium hydroxid; 130 grams sodium hydroxid.
21. Possoz:
40 grams copper sulfate; 300 grams potassium-sodium tartrate; 29 grams sodium hydroxid; 159 grams sodium bicarbonate, allow to stand six months before use. Fill to one liter. One cubic centimeter equals 0.0577 gram dextrose. One cubic centimeter equals 0.0548 gram cane sugar.
22. Rüth:
34.64 grams copper sulfate; 143 grams potassium-sodium tartrate; 600-700 cubic centimeters sodium hydroxid solution, 1.12 specific gravity. Fill to one liter.
23. Rodewald and Tollens:
34.639 grams copper sulfate, solution made up to half a liter; 173 grams potassium-sodium tartrate; 60 grams sodium hydroxid, solution made up to half a liter.
24. Schorlemmer:
34.64 grams copper sulfate; 200 grams potassium-sodium tartrate; 600-700 cubic centimeters sodium hydroxid solution, 1.20 specific gravity. Fill to one liter.
25. Soxhlet:
34.639 grams copper sulfate, solution made up to half a liter. 173 grams potassium-sodium tartrate; 51.6 grams sodium hydroxid, solution made up to half a liter.
26. Soldaini:
3.464 grams copper sulfate; 297 grams potassium bicarbonate. Fill to one liter.
27. Violette:
34.64 grams copper sulfate; 187.0 potassium-sodium tartrate; 78.0 sodium hydroxid made up to one liter. Ten cubic centimeters equal 0.050 gram dextrose. Ten cubic centimeters equal 0.0475 gram cane sugar.
117. Volumetric Method used in this Laboratory.—The alkaline copper solution preferred in this laboratory has the composition [Pg 130] proposed by Violette. The copper sulfate and alkaline tartrate solutions are kept in separate vessels and mixed in proper proportions immediately before use, and diluted with about three volumes of water. The reduction is accomplished in a long test tube at least twenty-five centimeters in length, and from thirty-five to forty millimeters in diameter.
The sugar solution employed should contain approximately one per cent of reducing sugar. If it should have a greater content it should be reduced with water to approximately the one named. If it have a less content, it should be evaporated in a vacuum at a low temperature until it reaches the strength mentioned above. A preliminary test will indicate almost the exact quantity of the sugar solution to be added to secure a complete reduction of the copper. This having been determined the whole quantity should be added at once to the boiling copper solution, the test tube held in the open flame of a lamp giving a large circular flame and the contents of the tube kept in brisk ebullition for just two minutes. The lamp is withdrawn and the precipitated suboxid allowed to settle. If a distinct blue color remain an additional quantity of the sugar solution is added and again boiled for two minutes. When the blue coloration is no longer distinct, the presence or absence of copper is determined by aspirating a drop or two of the hot solution with the apparatus described below. This clear filtered liquor is then brought into contact with a drop of potassium ferrocyanid solution acidulated with acetic. The production of a brown precipitate or color indicates that some copper is still present, in which case an additional quantity of the sugar solution is added and the operation continued as described above until after the last addition of sugar solution no coloration is produced.
118. The Filtering Tube.—The filtering tube used in the above operation is made of a long piece of narrow glass tubing with thick walls. The length of the tube should be from forty to forty-five centimeters. One end of the tube being softened in the flame is pressed against a block of wood so as to form a flange. Over this flange is tied a piece of fine linen.[82]
Instead of using a linen diaphragm the tube is greatly improved, as suggested by Knorr, by sealing into the end of the tube while hot a [Pg 131] perforated platinum disk. Before using, the tube is dipped into a vessel containing some suspended asbestos felt and by aspiration a thin felt of asbestos is formed over the outer surface of the platinum disk. By inverting the tube the water which has entered during aspiration is removed. The tube thus prepared is dipped into the boiling solution in the test tube above described and aspiration continued until a drop of the liquor has entered the tube. It is then removed from the boiling solution, the asbestos felt wiped off with a clean towel, and the drop of liquor in the tube blown through the openings in the platinum disk and brought into contact with a drop of potassium ferrocyanid in the usual way. In this way a drop of the liquor is secured without any danger of a reoxidation of the copper which may sometimes take place on cooling.

Figure 42. Apparatus for the Volumetric Estimation
of Reducing Sugars.
The careful analyst by working in this way with the volumetric method is able to secure highly accurate results. The apparatus used is shown in the accompanying illustration.
119. Suppression of the Error Caused by the Action of the Alkali on Reducing Sugars.—Three methods are proposed by Gaud for correcting or suppressing the error due to the action of the alkali upon reducing sugars. In the first place, the common method followed may be employed, depending upon the use of an alkaline copper solution of known composition and the employment of a reducing sugar solution of a strength varying between one-half and one per cent. The error which is introduced into such a reaction is a constant one and the solution [Pg 132] having been tested once for all against pure sugar is capable of giving fairly accurate results.
In the second place, a table may be constructed in which the error is determined for sugar solutions for varying strengths, viz., from one-tenth of one per cent to ten per cent. If y represent the error and x the exact percentage of reducing sugar present then the correction may be made by the following formula;
y = - 0.00004801x + 0.02876359x².
In order to use this formula in practice the percentage of reducing sugar obtained by the actual analysis must be introduced and may be represented by θ. The formula for correction then becomes 0.02876x² - 1.000048x + θ = 0; whence the value of x is easily computed.
In the third place, the error may be eliminated by substituting for an alkali which acts upon the glucose one which does not, viz., ammonia. At the temperature of boiling water ammonia does not have any decomposing effect upon reducing sugars. It is important, however, that the reduction take place in an inert atmosphere in order to avoid the oxidation of the dissolved cuprous oxid and the temperature need not be carried beyond 80°. The end of the reaction can be easily distinguished in this case by the disappearance of the blue color. When one reaction is finished the copper may be completely reoxidized by conducting through it a current of air or oxygen for half an hour, when an additional quantity of ammonia may be added to supply any that may have evaporated, and a new reduction accomplished with exactly the same quantity of copper as was used in the first. The solution used by Gaud contains 36.65 grams of crystallized copper sulfate dissolved in water and the volume completed to one liter with ordinary aqueous ammonia.[83]
120. Permanganate Process for the Estimation of Reducing Sugars.—Dextrose, invert sugar, and other reducing sugars can also be determined with a fair degree of accuracy by an indirect volumetric process, in which a standard solution of potassium permanganate is used as the final reagent.[84] The principle of the process is based upon the observation that two molecules [Pg 133] of dextrose reduce from an alkaline cupric tartrate solution five molecules of cuprous oxid. The five molecules of cuprous oxid thus precipitated when added to an acid solution of ferric sulfate, will change five molecules of the ferric sulfate to ten molecules of ferrous sulfate. The reaction is illustrated by the following equation:
| 5Cu₂O 715 parts |
+ | 5Fe₂(SO₄)₃ 2000 parts |
+ | 5H₂SO₄ 490 parts |
= | 10CuSO₄ 1595 parts |
| + | 10FeSO₄ 1520 parts |
+ | 5H₂O 90 parts |
The ten molecules of ferrous sulfate formed as indicated in the above reaction, are reoxidized to ferric sulfate by a set solution of potassium permanganate. This reaction is illustrated by the equation given below:
| 10FeSO₄ 1520 parts |
+ | K₂Mn₂O₈ 316.2 parts |
+ | 5H₂SO₄ 784 parts |
= | 5Fe₂(SO₄)₂ 2000 parts |
| + | 2MnSO₄ 302 parts |
+ | K₂SO₄ 174.2 parts |
+ | 8H₂O 144 parts |
By the study of the above equations it is seen that two molecules of dextrose or other similar reducing sugar, are equivalent to one molecule of potassium permanganate, as is shown by the following equations:
| 2C₆H₁₂O₆ 360 parts |
= | 5Cu₂O 715 parts |
= | 10FeSO₄ 1520 parts |
= | K₂Mn₂O₈ 316.2 parts |
It is thus seen that 316.2 parts by weight of potassium permanganate are equivalent to 360 parts by weight of dextrose; or one part of permanganate corresponds to 1.1385 parts by weight of dextrose. If, therefore, the amount of permanganate required in the above reaction to restore the iron to the ferric condition, be multiplied by the factor mentioned above, the quotient will represent in weight the amount of dextrose which enters into the reaction. The standard solution of potassium permanganate should contain 4.392 grams of the salt in a liter. One cubic centimeter of this solution is equivalent to five milligrams of dextrose.
121. Manipulation.—The saccharine solution whose strength is to be determined should contain approximately about one per cent of sugar. [Pg 134] Of this solution ten cubic centimeters are placed in a porcelain dish together with a considerable excess of fehling solution. When no sucrose is present, the mixture may be heated to the temperature of boiling water and kept at that temperature for a few minutes until all the reducing sugar is oxidized. There should be enough of the copper solution used to maintain a strong blue coloration at the end of the reaction. A greater uniformity of results will be secured by using in all cases a considerable excess of the copper solution. When sucrose or other non-reducing sugars are present, the temperature of the reaction should not be allowed to exceed 80° and the heating may be continued somewhat longer. At this temperature the copper solution is absolutely without action on sucrose. The precipitated suboxid is allowed to settle, the supernatant liquid poured off through a filter and the suboxid washed thoroughly a number of times by decantation with hot water, the washings being poured through the filter. This process of washing is greatly facilitated by decanting the supernatant liquid from the porcelain dish first into a beaker and from this into a third beaker and so on until no suboxid is carried off. Finally the wash water is poured through a filter-paper bringing as little as possible of the suboxid onto the paper. The suboxid on the filter-paper and in the beakers is next dissolved in a solution of ferric sulfate made strongly acid with sulfuric; or in a sulfuric acid solution of ammonia ferric sulfate which is more easily obtained free from impurities than the ferric sulfate. When all is dissolved from the beakers the solution is poured upon the suboxid which still remains in the porcelain dish. When the solution is complete it is washed into a half liter flask and all the vessels which contain the suboxid are also thoroughly washed and the wash waters added to the same flask. The whole is rendered strongly acid with sulfuric and made up to a volume of half a liter.
The process carried out as directed, when tested against pure sugar, gives good results, not varying from the actual content of the sugar by more than one-tenth per cent below or three-tenths above the true content. The distinct pink coloration imparted to the solution by the permanganate solution as soon as the iron is all oxidized to the ferric state marks sharply the end of the reaction. In this respect this [Pg 135] process is very much to be preferred to the usual volumetric processes depending upon the coloration produced with potassium ferrocyanid by a copper salt for distinguishing the end of the reaction. It is less convenient than the ordinary volumetric process by reason of the somewhat tedious method of washing the precipitated cuprous oxid. When a large number of analyses is to be made, however, the whole can be washed with no more expenditure of time than is required for a single sample. One analyst can, in this way, easily attend to fifty or a hundred determinations at a time.
In the application of the permanganate method to the analysis of the juices of sugar cane and sorghum it is directed to take 100 cubic centimeters of the expressed juice and clarify by the addition of twenty-five cubic centimeters of basic lead acetate, diluted with water, containing enough of the lead acetate, however, to produce a complete clarification. It is not necessary to remove the excess of lead from the filtrate before the determination. Ten cubic centimeters of the filtrate correspond to eight cubic centimeters of the original juice. For percentage calculation the specific gravity of the original juice must be known. Before the addition of the alkaline copper solution, from fifty to seventy-five cubic centimeters of water should be added to the clarified sugar juice and the amount of fehling solution used in each case should be from fifty to seventy-five cubic centimeters. The heating at 75° should be continued for half an hour in order to insure complete reduction and oxidation of the sugar. The sucrose can also be estimated in the same juices by inverting five cubic centimeters of the clarified juice with five cubic centimeters of dilute hydrochloric acid, by heating for an hour at a temperature not above 90°. Before adding the acid for inversion, about 100 cubic centimeters of water should be poured over the five cubic centimeters of sugar solution. The washing of the suboxid and the estimation of the amount reduced are accomplished in the manner above described.
This method has been extensively used in this laboratory and with very satisfactory results. The only practical objection which can be urged to it is in the time required for filtering. This fault is easily remedied by adopting the method of filtering through asbestos felt described in the next paragraph. [Pg 136]
For the sake of uniformity, however, the copper solution should be boiled for a few minutes before the addition of the sugar in order to expel all oxygen, the sugar solutions should be made with recently boiled water and the precipitation of the suboxid should be accomplished by heating for just thirty minutes at 75°. At the end of this time an equal volume of cold, recently boiled, water should be added and the filtration at once accomplished.
122. Modified Permanganate Method.—The permanganate method as used by Ewell, in this laboratory, is conducted as follows: After the precipitate is obtained, according to the directions given in the methods described, it is thoroughly washed with hot, recently boiled water, on a gooch. The asbestos, with as much of the precipitate as possible, is transferred to the beaker in which the precipitation was made, beaten up with from twenty-five to thirty cubic centimeters of hot, recently boiled water, and from fifty to seventy-five cubic centimeters of a saturated solution of ferric sulfate in twenty-five per cent sulfuric acid are added to the beaker and then poured through the crucible to dissolve the cuprous oxid remaining therein. If the precipitate be first beaten up with water as directed, so that no large lumps of it remain, there is no difficulty in dissolving the oxid in the ferric salt; while if any lumps of the oxid be allowed to remain there is great difficulty. After the solution is obtained, it is titrated with a solution of potassium permanganate of such a strength that each cubic centimeter is equivalent to 0.01 gram of copper.
In triplicate determinations made by this method the precipitates obtained required after solution in the ferric salt, 28.7, 28.9, 28.6 cubic centimeters of potassium permanganate solution, respectively. For the quantities taken this was equivalent to an average percentage of reducing sugars of 4.19. The percentage obtained by the gravimetric method was 4.26.
The method seems to be sufficiently accurate for all ordinary purposes and is extremely rapid.
The permanganate solution used should be standardized by means of metallic iron, but in ordinary work it is also recommended to standardize by check determinations of reducing sugars in the same sample by the gravimetric method. [Pg 137]
123. Determination of Reducing Sugar by the Specific Gravity of the Cuprous Oxid.—Gaud proposes to determine the percentage of reducing sugar from the specific gravity of the cuprous oxid. The manipulation is carried out as follows:
In a porcelain dish are placed fifty cubic centimeters of the alkaline copper solution and an equal quantity of water and the mixture maintained in ebullition for two or three minutes. The dish is then placed on a boiling water-bath and twenty-five cubic centimeters of a reducing sugar of approximately one per cent strength added at once. The reduction is thus secured at a temperature below 100°, which is an important consideration in securing the minimum decomposing effect of the alkali upon the sugar. The dish is kept upon the water-bath for about ten minutes when the reduction is complete and the supernatant liquor should still be intensely blue. The precipitate is washed by decantation with boiling water, taking care to avoid the loss of any of the cuprous oxid. The washing is continued until the wash waters are neutral to phenolphthalein. The cuprous oxid is then washed into a pyknometer of from twenty to twenty-five cubic centimeters capacity, the exact content of which has been previously determined at zero. It is filled with boiling water, the stopper inserted, and after cooling the flask is weighed. Let P be the weight of the pyknometer plus the liquid and the precipitate, the total volume of which is equal to the capacity of the flask at the temperature at which it was filled, that is Vₜ = V₀ [1 + 3β(t-t₀)].
This formula is essentially that given in paragraph 51, for calculating the volume of a pyknometer at any temperature, substituting for 3β, γ the cubical expansion of glass, viz., 0.000025.
The specific gravity of the dry cuprous oxid is Δ = 5.881 and let the specific gravity of water at the temperature of filling, which can be taken from any of the tables of the density of water, be d. The total weight p of the precipitated suboxid may then be calculated by the following formula:
| P = | P-Vₜ d | . | |
| 1 - | d | ||
| Δ | |||
The density of water at 99°, which is about the mean temperature of [Pg 138] boiling water for laboratories in general, is 0.95934, and this may be taken as the weight of one cubic centimeter for purposes of calculation in the formula above.
In order to obtain exact results, it is important that the weight P be reduced to a vacuum. The weight of cuprous oxid not varying proportionally to the weight of reducing sugar, it is necessary to prepare a table showing the principal numerical values of the two, in order to be able to calculate easily all the possible values, either directly from the table or by appropriate interpolations. Following are the chief values which are necessary for the calculation:
| Milligrams cuprous oxid. |
Milligrams dextrose. |
Milligrams cuprous oxid. |
Milligrams dextrose. |
|---|---|---|---|
| 10 | 5.413 | 100 | 46.221 |
| 20 | 9.761 | 200 | 91.047 |
| 30 | 14.197 | 300 | 138.842 |
| 50 | 23.036 | 400 | 188.928 |
It is claimed by the author that the above method is both simple and rapid and can be applied with an error of not more than one-thousandth if the corrections for temperature and pressure be rigorously applied.[85]
124. The Copper Carbonate Process.—While the copper solutions which have been mentioned in previous paragraphs have only a slight action on sucrose and dextrin yet on prolonged boiling even these bodies show a reducing effect due probably to a preliminary change in the sugar molecules whereby products analogous to dextrose or invert sugar are formed. In order to secure a reagent, to which the sugar not reducing alkaline copper solutions might be more resistant Soldaini has proposed to employ a liquor containing the copper as carbonate instead of as tartrate.[86] This solution is prepared by adding to a solution of forty grams of copper sulfate one of equal strength of sodium carbonate. The resulting copper carbonate and hydroxid are collected on a filter, washed with cold water, and dried. The reaction which takes place is represented by the following formula:
2CuSO₄ + 2Na₂CO₃ + H₂O =
CuCO₃ + CuO₂H₂ + 2Na₂SO₄ + CO₂.
The dry precipitate obtained, which will weigh about fifteen grams, is [Pg 139] placed in a large flask with about 420 grams of potassium bicarbonate and 1400 cubic centimeters of water. The contents of the flask are heated on a steam-bath for several hours with occasional stirring until the evolution of carbon dioxid has ceased. During this time the liquid is kept at the same volume by the addition of water, or by attaching a reflux condenser to the flask. The potassium and copper compounds at the end of this time will be found dissolved and the resulting liquor will have a deep blue color. After filtration the solution is boiled for a few minutes and cooled to room temperature. The volume is then completed to two liters. A more direct method of preparing the solution, and one quite as effective, consists in adding the solution of the copper sulfate directly to the hot solution of potassium bicarbonate and heating and shaking the mixture until the copper carbonate formed is dissolved. After filtering the volume is made as above. The proportions of reagents employed are placed by Preuss at 15.8 grams of crystallized copper sulfate and 594 grams of potassium bicarbonate.[87] The soldaini reagent is extremely sensitive and is capable of detecting as little as half a milligram of invert sugar. The presence of sucrose makes the reagent more delicate, and it is especially useful in determining the invert sugar arising during the progress of manufacture by the action of heat and melassigenic bodies on sucrose.
125. The Analytical Process.—As in the case of fehling solution a great many methods of conducting the analysis with the soldaini reagent have been proposed. The general principle of all these processes is the one already described for the alkaline copper tartrate solution, viz., the addition of the reducing sugar solution to the boiling reagent, and the determination of the end of the reaction by the disappearance of the copper.[88]
Practically, however, these methods have had no general application, and the use of the soldaini reagent has been confined chiefly to the determination of invert sugar in presence of a large excess of sucrose. For this purpose the sugar solution is not added until the blue color of the reagent has been destroyed, but on the other hand, the reagent has been used in excess, and the cuprous oxid formed collected and [Pg 140] weighed as metallic copper. The weight of the metallic copper found, multiplied by the factor 0.3546, gives the weight of invert sugar in the volume of the sugar solution used. According to Preuss, the factor is not a constant one, but varies with the quantity of invert sugar present, as is seen in the formula y = 2.2868 + 3.3x + 0.0041x², in which x = the invert sugar, and y the metallic copper.[89]
126. Tenth Normal Copper Carbonate Solution.—In the study of some of the solutions of copper carbonate, proposed for practical work, Ettore Soldaini was impressed with the difficulty of dissolving so large a quantity of carbonate in the solvent employed.[90] The solution recommended by Bodenbender and Scheller,[91] in which forty grams of the crystallized copper sulfate were used, failed to disclose an equivalent amount of copper in the reagent ready for use. For this reason a tenth-normal copper solution is prepared by Soldaini containing the equivalent of 3.464 grams of copper sulfate in one liter. The reagent is easily prepared by adding slowly the dissolved or finely powdered copper salt to a solution of 297 grams of potassium bicarbonate, and after complete solution of the copper carbonate formed, completing the volume to one liter. With this reagent as little as one-quarter of a milligram of reducing sugar can be easily detected. For the quantitive estimation of sugar a solution of the above strength is to be preferred to the other forms of the soldaini reagent by reason of the ease of direct comparison with standard fehling solutions.
The analytical process is conducted with the tenth-normal solution, prepared by Soldaini and described above, as follows: Place 100 cubic centimeters of the reagent in each of several porcelain dishes heat to boiling, and add little by little the sugar solution to one dish until the blue color has disappeared. Having thus determined nearly the exact quantity of sugar solution required for the copper in 100 cubic centimeters of the reagent the whole of the sugar solution is added at once, varying slightly the amounts added to each dish. The boiling is continued for fifteen minutes, and the contents of the dishes poured on filters. That filtrate which contains neither copper nor sugar represents the exact quantity of sugar solution which contained fifty milligrams of dextrose. [Pg 141]
127. Relation of Reducing Sugar to Quantity of Copper Suboxid Obtained.—The relation of the quantity of copper reduced to the amount of sugar oxidized by the copper carbonate solution has been determined by Ost, and the utility of the process thereby increased.[92] The solution used should have the following composition: 23.5 grams of crystallized copper sulfate, 250 grams of potassium carbonate, and 100 grams of potassium bicarbonate in one liter. Without an indicator the end reaction is distinctly marked by the passage of the blue color into a colorless solution. Ost affirms that this solution is preferable to any form of fehling liquor because it can be kept indefinitely unchanged; it attacks sucrose far less strongly, and an equal quantity of sugar precipitates nearly double the quantity of copper. The boiling requires a longer time, as a rule ten minutes, but this is a matter of no importance, when the other advantages are taken into consideration. The relations of the different sugars to the quantity of copper precipitated are given in the table in the next paragraph.
128. Factor for Different Sugars.—For pure dextrose the relation between sugar and copper reduced has been determined by Ost, and the data are given in the table below. The data were obtained by adding to fifty cubic centimeters of the copper solution twenty-five cubic centimeters of sugar solutions of varying strength and collecting, washing, and reducing the cuprous oxid obtained in a current of hydrogen in a glass tube by the method described further on.
The boiling in all cases was continued, just ten minutes, although a slight variation from the standard time did not produce so great a difference as with fehling reagent. In the case of dextrose, when fifty milligrams were used with fifty cubic centimeters of the solution, the milligrams of copper obtained after six, ten and twenty minutes’ boiling were 164.6, 165.5, and 166.9 respectively.[93]
The data differ considerably from those obtained by Herzfeld, but in his experiments the boiling was continued only for five minutes, [Pg 142] and this is not long enough to secure the proper reduction of the copper.[94]
Table Showing the Quantity of Copper
Reduced by Different Sugars.
| Copper. Milligrams |
Invert Sugar. Milligrams |
Dextrose. Milligrams |
Levulose. Milligrams |
Galactose. Milligrams |
Arabinose. Milligrams |
|---|---|---|---|---|---|
| 50 | 15.2 | 15.6 | 14.7 | 17.4 | 17.0 |
| 55 | 16.6 | 17.0 | 16.1 | 19.1 | 18.6 |
| 60 | 18.0 | 18.5 | 17.5 | 20.8 | 20.3 |
| 65 | 19.4 | 19.9 | 18.9 | 22.5 | 21.9 |
| 70 | 20.8 | 21.4 | 20.3 | 24.2 | 23.5 |
| 75 | 22.3 | 22.9 | 21.7 | 25.9 | 25.1 |
| 80 | 23.7 | 24.4 | 23.0 | 27.7 | 26.7 |
| 85 | 25.2 | 25.8 | 24.3 | 29.3 | 28.3 |
| 90 | 26.6 | 27.3 | 25.7 | 31.1 | 29.9 |
| 95 | 28.1 | 28.8 | 27.1 | 32.8 | 31.5 |
| 100 | 29.5 | 30.3 | 28.5 | 34.5 | 33.1 |
| 105 | 31.0 | 31.8 | 29.9 | 36.2 | 34.7 |
| 110 | 32.4 | 33.3 | 31.2 | 38.0 | 36.3 |
| 115 | 33.9 | 34.8 | 32.6 | 39.7 | 37.9 |
| 120 | 35.3 | 36.3 | 34.0 | 41.4 | 39.5 |
| 125 | 36.8 | 37.8 | 35.4 | 43.1 | 41.1 |
| 130 | 38.2 | 39.3 | 36.8 | 44.8 | 42.8 |
| 135 | 39.7 | 40.8 | 38.2 | 46.5 | 44.4 |
| 140 | 41.1 | 42.3 | 39.6 | 48.3 | 46.0 |
| 145 | 42.6 | 43.8 | 41.0 | 50.0 | 47.6 |
| 150 | 44.0 | 45.3 | 42.5 | 51.8 | 49.3 |
| 155 | 45.5 | 46.8 | 43.9 | 53.6 | 50.9 |
| 160 | 47.0 | 48.3 | 45.3 | 55.4 | 52.6 |
| 165 | 48.5 | 49.8 | 46.7 | 57.2 | 54.3 |
| 170 | 50.0 | 51.4 | 48.1 | 59.0 | 55.9 |
| 175 | 51.5 | 52.9 | 49.5 | 60.8 | 57.5 |
| 180 | 53.0 | 54.5 | 51.0 | 62.7 | 59.2 |
| 185 | 54.5 | 56.0 | 52.5 | 64.5 | 60.9 |
| 190 | 56.0 | 57.6 | 54.0 | 66.4 | 62.7 |
| 195 | 57.5 | 59.2 | 55.5 | 68.3 | 64.4 |
| 200 | 59.1 | 60.8 | 57.0 | 70.3 | 66.2 |
| 205 | 60.7 | 62.4 | 58.6 | 72.3 | 68.0 |
| 210 | 62.4 | 64.1 | 60.2 | 74.3 | 69.8 |
| 215 | 64.1 | 65.8 | 61.8 | 76.3 | 71.6 |
| 220 | 65.8 | 67.5 | 63.5 | 78.3 | 73.5 |
| 225 | 67.5 | 69.2 | 65.2 | 80.3 | 75.4 |
| 230 | 69.3 | 70.9 | 66.9 | 82.4 | 77.3 |
| 235 | 71.1 | 72.7 | 68.7 | 84.5 | 79.3 |
| 240 | 72.9 | 74.5 | 70.6 | 86.6 | 81.3 |
| 245 | 74.8 | 76.4 | 72.5 | 88.9 | 83.4 |
| 250 | 76.7 | 78.4 | 74.4 | 91.2 | 85.5 |
| 255 | 78.6 | 80.5 | 76.5 | 93.5 | 87.6 |
| 260 | 80.5 | 82.8 | 78.8 | 95.9 | 89.8 |
| 265 | 82.5 | 85.1 | 81.1 | 98.3 | 92.2 |
| 270 | 84.7 | 87.5 | 83.5 | 100.7 | 94.6 |
| 275 | 87.1 | 89.9 | 85.9 | 103.3 | 97.1 |
| 280 | 89.7 | 92.4 | 88.6 | 106.1 | 99.6 |
| 285 | 92.3 | 94.9 | 91.3 | 109.0 | 102.3 |
| 290 | 95.1 | 97.6 | 94.2 | 112.0 | 105.1 |
| 295 | 98.0 | 100.4 | 97.2 | 115.1 | 107.9 |
| 298 | 100.0 | 102.5 | 99.0 | 117.0 | 109.5 |
129. Pavy’s Process.—The well-known solubility of cuprous oxid in ammonia led Pavy to adopt a copper reagent containing ammonia in the volumetric determination of reducing sugars.[95] In Pavy’s process an alkaline copper solution is employed made up in the usual way, to which a sufficient quantity of ammonia is added to hold in solution all the copper when precipitated as cuprous oxid. The solution used by Pavy has the following composition: One liter contains
| Crystallized copper sulfate | 34.65 | grams |
| Potassium-sodium tartrate | 173.00 | ” |
| Caustic potash | 160.00 | ” |
For use 120 cubic centimeters of the above reagent are mixed with 300 of ammonia of specific gravity 0.88, and the volume completed to one liter with distilled water. Twenty cubic centimeters of this reagent are equivalent to ten milligrams of dextrose or invert sugar when added in a one per cent solution.
In the use of ammoniacal copper solution, care must be taken that all the liquids employed be entirely free of oxygen and that the contents of the flask in which the reduction takes place be in some way excluded from contact with the air. Pavy secured this by conducting the reduction in a flask closed with a stopper carrying two holes; one of these served for the introduction of the burette carrying the sugar solution and the other carried a tube dipping into a water seal by means of a slit rubber tube, which would permit of the exit of the vapors of steam and ammonia, but prevent the regurgitation of the water into the flask.
The complete decoloration of the copper solution marks the end of the reaction. The usual precautions in regard to the length of the time of boiling must be observed.
It is easy to see that in the Pavy process the quantity of ammonia in the solution is rapidly diminished during the boiling and this has led to the suggestion of other methods to exclude the air. Among these have been recommended the introduction of a current of hydrogen or carbon dioxid. One of the best methods of procedure is that proposed by Allen, [Pg 144] who recommends covering the copper solution by a layer of paraffin oil (kerosene).[96]
130. Process Of Peska.—Peska has also independently made use of Allen’s method of covering the solutions with a layer of paraffin oil and finds it reliable.[97] The copper reagent employed by him has the following composition:
| Crystallized copper sulfate | 6.927 | grams |
| Ammonia, twenty-five per cent strength | 160.00 | cc. |
The copper sulfate is dissolved in water, the ammonia added, and the volume completed to half a liter with distilled water. A second solution containing half a liter is made by dissolving 34.5 grams of potassium-sodium tartrate and ten grams of sodium hydroxid and completing the cool solution to half a liter with distilled water. In all cases the water used in making up the above solutions must be freshly boiled to exclude the air.
For the titration, fifty cubic centimeters of each of the above solutions are taken, mixed and covered with a layer of paraffin oil half a centimeter in depth. The reduction is not accomplished at a boiling temperature, but at from 80° to 85°. The manipulation is conducted as follows:
The mixed solutions are placed in a beaker, covered with oil, and heated to 80°. The temperature is measured by a thermometer which also serves as a stirring rod. The sugar solution is run down the sides of the beaker from a burette of such a shape as to be protected from the heat. After each addition of the sugar solution the mixture is carefully stirred, keeping the temperature at from 80° to 85°. The first titration is made to determine approximately the quantity of sugar solution necessary to decolorize the copper. This done, the actual titration is accomplished by adding at once the total amount of sugar solution necessary to decolorize, less about one cubic centimeter. Any sugar solution adhering to the side of the beaker is washed down by distilled water, the contents of the beaker well stirred, and the temperature kept at 85° for two minutes. The rest of the sugar solution is then added in quantities of one-tenth of a cubic centimeter until the decoloration is completed. The total time of the final titration should not exceed five minutes. The sugar solution should be as nearly as possible of one per cent strength. If a lower [Pg 145] degree of strength be employed a larger quantity of the sugar is necessary to reduce a given quantity of copper.
In the case of dextrose, when a one per cent solution is used, eight and two-tenths cubic centimeters, corresponding to 80.2 milligrams of dextrose, are required to reduce 100 cubic centimeters of the mixed reagent. On the other hand, when the sugar solution is diluted to one-tenth of a per cent strength 82.1 milligrams are required.
With invert sugar slightly larger quantities are necessary, the reducing power being as 94.9 to 100 as compared with dextrose. With a one per cent strength of invert sugar it is found that eighty-four milligrams are required to reduce 100 cubic centimeters of the mixed reagent and when the strength of the invert sugar is reduced to one-tenth per cent 87.03 milligrams are required.
131. Method Of Allein and Gaud.—Allein and Gaud have proposed a further modification of the ammonia process which consists essentially in the suppression of rochelle salt and fixed caustic alkali and the entire substitution therefor of ammonia. Ammonia acts with much less vigor upon sugars than the caustic alkalies, and it is therefore claimed that the decomposition of the sugar due to the alkali is reduced to a minimum when ammonia is employed.[98] The copper solution is made as follows:
Dissolve 8.7916 grams of electrolytic copper in ninety-three grams of concentrated sulfuric acid diluted with an equal volume of water. Complete the resulting solution to one liter with concentrated ammonia. Ten cubic centimeters of this solution are equal to fifty grams of dextrose.
It is recommended that the reduction be accomplished in an atmosphere of hydrogen, but it is apparent that the use of kerosene is permissible in this case, and on account of its greater simplicity it is to be recommended as the best means of excluding the oxygen. The reduction is accomplished at a temperature of about 80°.
It is also proposed to reoxidize the copper by substituting a current of air for the hydrogen at the end of the reaction, and thus use the same copper a number of times. The danger of loss of ammonia, and the [Pg 146] difficulty of determining when the oxidation is complete, render this regeneration of the reagent undesirable.
132. Method of Gerrard.—The method of Gerrard does not depend upon the use of ammonia, but the principle involved is the same, viz., the holding of the separated cuprous oxid in solution and the determination of the end of the reaction by the disappearance of the blue color. As first proposed by Gerrard, the copper sulfate solution is made of double the strength usually employed and to each 100 cubic centimeters thereof, before use, three and three-tenths grams of potassium cyanid are added. This is sufficient to hold the precipitated cuprous oxid in solution.[99]
The original method of Gerrard is found difficult of execution and the author, in conjunction with Allen, has lately modified it and reduced it to a practical working basis.[100]
In the new method the ordinary fehling solution is employed and it is prepared for use in the following way: Ten cubic centimeters of the fehling solution, or half that quantity of each of the component parts kept in separate bottles, are placed in a porcelain dish with forty cubic centimeters of water and brought to the boiling-point. To the boiling liquid is added, from a pipette, a five per cent solution of potassium cyanid until the blue color just disappears, or only a very faint tint of blue remains, avoiding any excess of the cyanid. A second portion of the fehling solution equal to that first employed is added, and to the boiling mixture the solution of sugar is added, from a burette, until the blue color disappears. The contents of the dish should be kept boiling during the addition of the sugar solution. The volume used will contain fifty milligrams of dextrose. The sugar solution should be of such a strength as to contain no more than half a per cent of reducing sugar.
The principle of the preparation of the solution may be stated as follows: If to a solution of copper sulfate, potassium be added until the blue color disappears, a double cyanid of copper and potassium cyanid is formed according to the following reaction:
CuSO₄ + 4KCN = Cu(CN)₂.2KCN + K₂SO₄.
This double cyanid is a salt of considerable stability. It is not decomposed by alkalies, hydrogen or ammonium, [Pg 147] sulfid. With mineral acids it gives a whitish, curdy precipitate. With fehling solution the same double cyanid is formed as that described above. If, however, fehling solution be present in excess of the amount necessary to form the double cyanid of copper, this excess can be used in the oxidation of reducing sugar and the colorless condition of the solution will be restored as soon as the excess of the fehling is destroyed. The double cyanid holds in solution the cuprous oxid formed and thus complete decoloration is secured.
133. Sidersky’s Modification of Soldaini’s Process.—In all cases where the sugar solutions are not too highly colored, Sidersky finds that the method of reduction in a large test tube, as practiced by Violette, is applicable with the copper carbonate solution.[101] For more exact work it is preferred to determine the quantity of copper reduced by an indirect volumetric method. The sugar solution, properly clarified and the lead removed if subacetates have been used, is made of such a volume as to contain less than one per cent of reducing sugars. In a flask or large test tube are placed 100 cubic centimeters of the copper solution, which is boiled for a short time and the sugar solution added, little by little, from a pipette, at such a rate as not to stop the ebullition. The boiling is continued for five minutes after the last addition of the sugar. The vessel is taken from the flame and 100 cubic centimeters of cold water added, the whole brought on an asbestos felt and the cuprous oxid washed with hot water until the alkaline reaction has disappeared. The residual cuprous oxid is dissolved in a measured quantity of set sulfuric acid, semi- or fifth-normal, a few particles of potassium chlorate added, and the mixture boiled to convert any cuprous into cupric sulfate. The reaction is represented by the following formula:
3Cu₂O + 6H₂SO₄ + KClO₃ = 6CuSO₄ + KCl + 6H₂O.
The residual sulfuric acid is titrated with a set alkali in excess, ammonia being preferred.
The solution of ammonia is made by diluting 200 cubic centimeters of commercial aqua ammonia with 800 of water. Its strength is determined by adding a little copper sulfate solution as indicator and then the set solution of sulfuric acid until the blue color disappears. The [Pg 148] copper sulfate secured from the cuprous sulfate as described above is cooled, and a quantity of the ammonia, equal to twenty-five cubic centimeters of the set sulfuric acid, added. The excess of the ammonia is then determined by titration with the sulfuric acid, the disappearance of the blue color being the indication of the end of the reaction. The number of cubic centimeters of the set sulfuric acid required to saturate the ammonia represents the equivalent of cuprous oxid originally present. One cubic centimeter of normal sulfuric acid is equivalent to 0.0317 gram of metallic copper.
To determine the weight of invert sugar oxidized, multiply the weight of copper, calculated as above described, by the factor 0.3546.[102] For a general application of this method of analysis the relative quantities of copper reduced by different quantities of sugar must be taken into consideration.
While, as has already been stated, the copper carbonate process has heretofore been applied chiefly to the detection of invert sugar, it has merits which justify the expectation that it may some time supplant the fehling liquor both for volumetric and gravimetric work. Large volumes of the reagent can be prepared at once and without danger of subsequent change. The action of the reagent on the hexobioses and trioses is far less vigorous than that of the alkaline copper tartrate, and the end reactions for volumetric work are, at least, as easily determined in the one case as the other.
134. Method Depending on Titration of Excess of Copper.—Instead of measuring the quantity of copper reduced, either by its disappearance or by reducing the cuprous oxid to a metallic state, Politis has proposed a method of analysis depending on the titration of the residual copper.[103] The reagents employed are:
(1) A copper solution containing 24.95 grams of crystallized copper sulfate, 140 grams of sodium and potassium tartrate, and twenty-five grams of sodium hydroxid in one liter:
(2) A solution of sodium thiosulfate containing 24.8 grams of the salt in one liter:
(3) A solution of potassium iodid containing 12.7 grams of iodin in one liter.
[Pg 149] The reaction is represented by the formula
2CuCl₂ + 4KI = Cu₂I₂ + 4KCl + I₂.
The analytical process is carried out as follows: In a 100 cubic centimeter flask are boiled fifty cubic centimeters of the copper solution, ten cubic centimeters of about one-tenth per cent reducing sugar solution are added, the boiling continued for five minutes, the flask filled to the mark with boiling water and its contents filtered. Fifty cubic centimeters of the hot filtrate are cooled, slightly acidified, potassium iodid solution added in slight excess; and the iodin set free determined by titration with sodium thiosulfate. The quantity of iodin obtained corresponds to the unreduced copper remaining after treatment with the reducing sugar. The number of cubic centimeters of thiosulfate used subtracted from twenty-five will give the number of cubic centimeters of the copper solution which would be reduced by five cubic centimeters of the sugar solution used.
Example.—In the proportions given above it was found that eleven cubic centimeters of thiosulfate were required to saturate the iodin set free. Then 25 - 11 = 14 cubic centimeters of copper solution reduced by five cubic centimeters of the sugar solution. Since one cubic centimeter of the copper solution is reduced by 0.0036 gram of dextrose the total dextrose in the five cubic centimeters = 0.0036 × 5 = 0.0180 gram.
The above method does not seem to have any practical advantage over those based on noting the disappearance of the copper and is given only to illustrate the principle of the process. While the titration of the iodin by sodium thiosulfate is easily accomplished in the absence of organic matter, it becomes difficult, as shown by Ewell, when organic matters are present, as they always are in the oxidation of a sugar solution. Ewell has therefore proposed to determine the residual copper by a standard solution of potassium cyanid, but the method has not yet been developed.[104]
135. General Principles.—In the preceding pages the principles of the volumetric methods of sugar analysis by means of alkaline copper [Pg 150] solution have been set forth. They depend either on the total decomposition of the copper solution employed by the reducing sugar, or else on the collection and titration of the cuprous oxid formed in the reaction. In the gravimetric methods the general principle of the process rests upon the collection of the cuprous oxid formed and its reduction to metallic copper, the weight of which serves as a starting point in the calculations of the weight of reducing sugar, which has been oxidized in the solution.
The factors which affect the weight of copper obtained are essentially those which influence the results in the volumetric method. The composition of the copper solution, the temperature at which the reduction is accomplished, the time of heating, the strength of the sugar solution and the details of the manipulation, all affect more or less the quantity of copper obtained. As in the volumetric method also, the kind of reducing sugar must be taken in consideration, dextrose, levulose, invert sugar, maltose and other sugars having each a definite factor for reduction in given conditions. It follows, therefore, that only those results are of value which are obtained under definite conditions, rigidly controlled.
136. Gravimetric Methods of the Department of Agriculture Laboratory.—The process used in this laboratory is based essentially on the methods of Maercker, Behrend, Morgen, Meissl, Hiller and Allihn.[105] Where dextrose alone is present, the table of factors proposed by Allihn is used and also the copper solution corresponding thereto.
For pure invert sugar, the tables and solutions of Meissl are used. For invert sugar in the presence of sucrose, the table and process proposed by Hiller are used. [Pg 151]

Figure 43. Apparatus for the Electrolytic Deposition of Copper.
[Pg 152] The reduction of the copper solution and the electrolytic deposition of the copper are accomplished as follows:
The copper and alkali solutions are kept in separate bottles. After mixing the equivalent volume of the two solutions in a beaker, heat is applied and the mixture boiled. To the boiling liquid the proper volume of the cold sugar solution is added. This must always be less than the amount required for complete reduction. The solution is again brought into ebullition and kept boiling exactly two minutes. A two-minute sand glass is conveniently used to determine the time of boiling. At the end of this time an equal volume of freshly boiled cold water is added, and the supernatant liquor at once passed through a gooch under pressure. The residual cuprous oxid is covered with boiling water and washed by decantation until the wash water is no longer alkaline. It is more convenient to wash in such a way that, at the end, the greater part of the cuprous oxid is in the gooch. The felt and cuprous oxid are then returned to the beaker in which the reduction is made. The gooch is moistened with nitric acid to dissolve any adhering oxid and then is washed into the beaker. Enough nitric acid is added to bring all the oxid into solution, an excess being avoided, and a small amount of water added. The mixture is again passed under pressure through a gooch having a thin felt, to remove the asbestos and the filtrate collected in a flask of about 150 cubic centimeters capacity. The washing is continued until the gooch is free of copper, when the volume of the filtrate should be about 100 cubic centimeters. The liquid is transferred to a platinum dish holding about 175 cubic centimeters and the flask washed with about twenty-five cubic centimeters of water. From three to five cubic centimeters of strong sulfuric acid are added and the copper deposited by an electric current.
137. Precipitating the Copper.—When no more nitric acid is used than indicated in the previous paragraph, it will not be necessary to remove it by evaporation. The platinum dishes containing the solutions of the cuprous oxid are arranged as shown in the figure for the precipitation of the copper by the electric current. Each of the supporting stands has its base covered with sheet-copper, on which the platinum dishes rest. The uprights are made of heavy glass rods and carry the supports for the platinum cylinders which dip into the copper solutions. The current used is from the city service and is brought in through the lamp shown at the right of the figure. This current has a voltage of about 120. After passing the lamp it is conducted through the regulator shown at the right, a glass tube closed below by a stopper carrying a piece of platinum foil, and above by one holding a glass tube, in the lower end of which is sealed a piece of sheet [Pg 153] platinum connected, through the glass tube, with the lamp. The regulating tube contains dilute sulfuric acid. The strength of current desired is secured by adjusting the movable pole. A battery of this kind easily secures the precipitation of sixteen samples at once, but only twelve are shown in the figure. The practice here is to start the operation at the time of leaving the laboratory in the afternoon. The next morning the deposition of the copper will be found complete. The wiring of the apparatus is shown in the figure. The wire from the regulator is connected with the base of the first stand, and thence passes through the horizontal support to the base of the second, and so on. The return to the lamp is accomplished by means of the upper wire. This plan of arranging the apparatus has been used for two years, and with perfect satisfaction.
Where a street current is not available, the following directions may be followed: Use four gravity cells, such as are employed in telegraphic work, for generating the current. This will be strong enough for one sample and by working longer for two. Connect the platinum dish with the zinc pole of the battery. The current is allowed to pass until all the copper is deposited. Where a larger number of samples is to be treated at once, the size of the battery must be correspondingly increased.
138. Method Used at the Halle Station.—The method used at the Halle station is the same as that originally described by Maercker for dextrose.[106] The copper solution employed is the same as in the allihn method, viz., 34.64 grams of copper sulfate in 500 cubic centimeters, and 173 grams of rochelle salt and 125 grams of potassium hydroxid in the same quantity of water. In a porcelain dish are placed thirty cubic centimeters of copper solution and an equal quantity of the alkali, sixty cubic centimeters of water added and the mixture boiled. To the solution, in lively ebullition, are added twenty-five cubic centimeters of the dextrose solution to be examined which must not contain more than one per cent of sugar. The mixture is again boiled and the separated cuprous oxid immediately poured into the filter and washed with hot water, until the disappearance of an alkaline reaction. For [Pg 154] filtering, a glass tube is employed, provided with a platinum disk, and resembling in every respect similar tubes used for the extraction of substances with ether and alcohol. The arrangement of the filtering apparatus is shown in Fig. 44. In the Halle method it is recommended that the tubes be prepared by introducing a platinum cone in place of the platinum disk and filling it with asbestos felt, pressing the felt tightly against the sides of the glass tube and making the asbestos fully one centimeter in thickness. This is a much less convenient [Pg 155] method of working than the one described above. After filtration and washing, the cuprous oxid is washed with ether and alcohol and dried for an hour at 110°, and finally reduced to metallic copper in a stream of pure dry hydrogen, heat being applied by means of a small flame. The apparatus for the reduction of the cuprous oxid is shown in Fig. 45. The metallic copper, after cooling and weighing, is dissolved in nitric acid, the tube washed with water, ether and alcohol, and again dried, when it is ready for use a second time. The percentage of dextrose is calculated from the milligrams of copper found by Allihn’s table.

Figure 44. Apparatus for Filtering Copper Suboxid.

Figure 45. Apparatus for Reducing Copper Suboxid.
139. Tables for Use in the Gravimetric Determination of Reducing Sugars.—The value of a table for computing the percentage of a reducing sugar present in a solution, is based on the accuracy with which the directions for the determination are followed. The solution must be of the proper strength and made in the way directed. The degree of dilution prescribed must be scrupulously preserved and the methods of boiling during reduction and washing the reduced copper, followed. The quantity of copper obtained by the use of different alkaline copper solutions and of sugar solutions of a strength different from that allowed by the fixed limits, is not a safe factor for computation. It must be understood, therefore, that in the use of the tables the directions which are given are to be followed in every particular.
140. Allihn’s Gravimetric Method for the Determination of Dextrose.—Reagents:
| I. | 34.639 grams of CuSO₄.5H₂O, | dissolved in water and diluted to half a liter: |
| II. | 173 grams of rochelle salts | dissolved in water and diluted |
| 125 grams of KOH, | to half a liter. |
Manipulation: Place thirty cubic centimeters of the copper solution (I), thirty cubic centimeters of the alkaline tartrate solution (II), and sixty cubic centimeters of water in a beaker and heat to boiling. Add twenty-five cubic centimeters of the solution of the material to be examined, which must be so prepared as not to contain more than one per cent of dextrose, and boil for two minutes. [Pg 156] Filter immediately after adding an equal volume of recently boiled cold water and obtain the weight of copper by one of the gravimetric methods given. The corresponding weight of dextrose is found by the following table:
Allihn’s Table for the
Determination of Dextrose.
141. Meissl’s Table for Invert Sugar.—Invert sugar is usually the product of the hydrolysis of sucrose. The following table is to be used when the hydrolysis is complete, i. e., when no sucrose is left in the solution. The solution of copper sulfate and of the alkaline tartrate are made up as follows: 34.64 grams of copper sulfate in half a liter, and 173 grams of rochelle salt and 51.6 grams sodium hydroxid in the same volume. The quantity of sugar solution used must not contain more than 245 nor less than ninety milligrams of invert sugar.
In the determination twenty-five cubic centimeters of the copper solution and an equal volume of the alkaline tartrate are mixed and boiled, the proper amount of sugar solution added to secure a quantity of invertose within the limits named, the volume completed to 100 cubic centimeters with boiling water, and the mixture kept in lively ebullition for two minutes. An equal volume of recently boiled cold water is added and the cuprous oxid at once separated by filtration on asbestos under pressure, and washed free of alkali with boiling water. The metallic copper is secured by one of the methods already described. [Pg 159]
Table for Invert Sugar by Meissl and Wien.[107]
[Pg 161] 142. Table for the Determination of Invert Sugar (Reducing Sugars) in the Presence of Sucrose.—The method adopted by the Association of Official Agricultural Chemists is essentially that proposed by Meissl and Hiller.[108] Prepare a solution of the material to be examined in such a manner that it contains twenty grams of the mixed sugars in one hundred cubic centimeters, after clarification and the removal of the excess of lead. Prepare a series of solutions in large test tubes by adding one, two, three, four, five etc. cubic centimeters of this solution to each tube successively. Add five cubic centimeters of the mixed copper reagent to each, heat to boiling, boil two minutes and filter. Note the volume of sugar solution which gives the filtrate lightest in tint, but still distinctly blue. Place twenty times this volume of the sugar solution in a 100 cubic centimeter flask, dilute to the mark, and mix well. Use fifty cubic centimeters of the solution for the determination, which is conducted as already described, until the weight of copper is obtained. For the calculation of the results use the following formulas and table of factors of Meissl and Hiller:[109]
| Let Cu = | the weight of the copper obtained; |
| P = | the polarization of the sample; |
| W = | the weight of the sample in the fifty cubic |
| centimeters of the solution used for determination; | |
| F = | the factor obtained from the table for conversion |
| of copper to invert sugar; | |
| Cu | = approximate absolute weight of invert sugar = Z; |
| 2 | |
| 100 | |
| Z × —— = | approximate per cent of invert sugar = y; |
| W | |
| 100P | = R, relative number for sucrose; |
| P + y | |
| 100 - R = | I, relative number for invert sugar; |
| Cu | = per cent of invert sugar. |
| W |
Z indicates the vertical column, and the ratio of R to I, the horizontal column of the table, which are to be used for the purpose of finding the factor (F) for calculating copper to invert sugar. [Pg 162]
Example:—The polarization of a sugar is 86.4, and 3.256 grams of it (W) are equivalent to 0.290 gram of copper. Then:
| Cu | = | 0.290 | = 0.145 = Z |
| 2 | 2 |
| Z × | 100 | = 0.145 × | 100 | = 4.45 = y |
| W | 3.256 |
| 100P | = | 8640 | = 95.1 = R |
| P + y | 86.4 + 4.45 |
100 - R = 100 - 95.1 = 4.9 = I
R : I = 95.1 : 4.9
By consulting the table it will be seen that the vertical column headed I = 150 is nearest to Z, 145, the horizontal column headed 95: 5 is nearest to the ratio of R to I, 95.1: 4.9. Where these columns meet we find the factor 51.2, which enters into the final calculation:
| CuF | = | .290 × 51.2 | = 4.56 the true per cent of invert sugar. |
| W | 3.256 |
Meissl and Hiller’s Factors for the Determination of
More Than One Per Cent of Invert Sugar.
| Ratio of sucrose to invert sugar = |
Approximate absolute weight of invert sugar = Z. | ||||||
|---|---|---|---|---|---|---|---|
| I = 200 | I = 175 | I = 150 | I = 125 | I = 100 | I = 75 | I = 50 | |
| R : I. | mg. | mg. | mg. | mg. | mg. | mg. | mg. |
| 0 : 100 | 56.4 | 55.4 | 54.5 | 53.8 | 53.2 | 53.0 | 53.0 |
| 10 : 90 | 56.3 | 55.3 | 54.4 | 53.8 | 53.2 | 52.9 | 52.9 |
| 20 : 80 | 56.2 | 55.2 | 54.3 | 53.7 | 53.2 | 52.7 | 52.7 |
| 30 : 70 | 56.1 | 55.1 | 54.2 | 53.7 | 53.2 | 52.6 | 52.6 |
| 40 : 60 | 55.9 | 55.0 | 54.1 | 53.6 | 53.1 | 52.5 | 52.4 |
| 50 : 50 | 55.7 | 54.9 | 54.0 | 53.5 | 53.1 | 52.3 | 52.2 |
| 60 : 40 | 55.6 | 54.7 | 53.8 | 53.2 | 52.8 | 52.1 | 51.9 |
| 70 : 30 | 55.5 | 54.5 | 53.5 | 52.9 | 52.5 | 51.9 | 51.6 |
| 80 : 20 | 55.4 | 54.3 | 53.3 | 52.7 | 52.2 | 51.7 | 51.3 |
| 90 : 10 | 54.6 | 53.6 | 53.1 | 52.6 | 52.1 | 51.6 | 51.2 |
| 91 : 9 | 54.1 | 53.6 | 52.6 | 52.1 | 51.6 | 51.2 | 50.7 |
| 92 : 8 | 53.6 | 53.1 | 52.1 | 51.6 | 51.2 | 50.7 | 50.3 |
| 93 : 7 | 53.6 | 53.1 | 52.1 | 51.2 | 50.7 | 50.3 | 49.8 |
| 94 : 6 | 53.1 | 52.6 | 51.6 | 50.7 | 50.3 | 49.8 | 48.9 |
| 95 : 5 | 52.6 | 52.1 | 51.2 | 50.3 | 49.4 | 48.9 | 48.5 |
| 96 : 4 | 52.1 | 51.2 | 50.7 | 49.8 | 48.9 | 47.7 | 46.9 |
| 97 : 3 | 50.7 | 50.3 | 49.8 | 48.9 | 47.7 | 46.2 | 45.1 |
| 98 : 2 | 49.9 | 48.9 | 48.5 | 47.3 | 45.8 | 43.3 | 40.0 |
| 99 : 1 | 47.7 | 47.3 | 46.5 | 45.1 | 43.3 | 41.2 | 38.1 |
[Pg 163] 143. Table for the Estimation of Milk Sugar.—The solutions to be used for this table are the same as those employed in the preceding table for the estimation of invert sugar. The milk sugar is supposed to be in a pure form in solution before beginning the analysis. The method to be employed for milk will be given in the part devoted to dairy products.
In the conduct of the work twenty-five cubic centimeters of the copper solution are mixed with an equal quantity of the alkaline tartrate mixture, and from twenty to one hundred cubic centimeters of the sugar solution added, according to its concentration. This solution should not contain less than seventy nor more than 306 milligrams of lactose. The volume is completed to 150 cubic centimeters with boiling water and kept in lively ebullition for six minutes. The rest of the operation is conducted in the manner already described. From the weight of copper obtained the quantity of milk sugar is determined by inspecting the table. It is recommended to use such a weight of milk sugar as will give about 200 milligrams of copper.
Table for Determining Milk Sugar.
144. Table for the Determination of Maltose.—The copper and alkaline solutions employed for the oxidation of maltose are the same as those used for invert and milk sugars.
In the manipulation twenty-five cubic centimeters each of the copper and alkali solutions are mixed and boiled and an equal volume of the maltose solution added, which should not contain more than one per cent of the sugar. The boiling is continued for four minutes, an equal volume of cold recently boiled water added, the cuprous oxid separated by filtration and the metallic copper obtained in the manner already described. The weight of maltose oxidized is then ascertained from the table.
Table for Maltose.
145. Preparation of Levulose.—It is not often that levulose, unmixed with other reducing sugars, is brought to the attention of the analyst. It probably does not exist in the unmixed state in any agricultural product. The easiest method of preparing it is by the hydrolysis of inulin. A nearly pure levulose has also lately been placed on the market under the name of diabetin. It is prepared from invert sugar.
Inulin is prepared from dahlia bulbs by boiling the pulp with water and a trace of calcium carbonate. The extract is concentrated to a sirup and subjected to a freezing temperature to promote the crystallization of the inulin. The separated product is subjected to the above operations several times until it is pure and colorless. It is then washed with alcohol and ether and is reduced to a fine powder. Before the repeated treatment with water it is advisable to clarify the solution with lead subacetate. The lead is afterwards removed by hydrogen sulfid and the resultant acetic acid neutralized with calcium carbonate.
By the action of hot dilute acids inulin is rapidly converted into levulose.
Levulose may also be prepared from invert sugar, but in this case it [Pg 168] is difficult to free it from traces of dextrose. The most successful method consists in forming a lime compound with the invert sugar and separating the lime levulosate and dextrosate by their difference in solubility. The levulose salt is much less soluble than the corresponding compound of dextrose. In the manufacture of levulose from beet molasses, the latter is dissolved in six times its weight of water and inverted with a quantity of hydrochloric acid, proportioned to the quantity of ash present in the sample. After inversion the mixture is cooled to zero and the levulose precipitated by adding fine-ground lime. The dextrose and coloring matters in these conditions are not thrown down. The precipitated lime levulosate is separated by filtration and washed with ice-cold water. The lime salt is afterwards beaten to a cream with water and decomposed by carbon dioxid. The levulose, after filtration, is concentrated to the crystallizing point.[110]
146. Estimation of Levulose.—Levulose, when free of any admixture with other reducing sugars, may be determined by the copper method with the use of the subjoined table, prepared by Lehmann.[111] The copper solution is the same as that used for invert sugar, viz., 69.278 grams of pure copper sulfate in one liter. The alkali solution is prepared by dissolving 346 grams of rochelle salt and 250 grams of sodium hydroxid in water and completing the volume to one liter.
Manipulation.—Twenty-five cubic centimeters of each solution are mixed with fifty of water and boiled. To the boiling mixture twenty-five cubic centimeters of the levulose solution are added, which must not contain more than one per cent of the sugar. The boiling is then continued for fifteen minutes, and the cuprous oxid collected, washed and reduced to the metallic state in the usual way. The quantity of levulose is then determined by inspection from the table given below. Other methods of determining levulose in mixtures will be given further on. [Pg 169]
Table for the Estimation of Levulose.
147. Precipitation of Sugars with Phenylhydrazin.—The combination of phenylhydrazin with aldehyds and ketones was first studied by Fischer, and the near relationship of these bodies to sugar soon led to the investigation of the compounds formed thereby with this reagent.[112] Reducing sugars form with phenylhydrazin insoluble crystalline bodies, to which the name osazones has been given. The reaction which takes place is a double one and is represented by the following formulas:
The dextrosazone is commonly called glucosazone. The osazones formed with the commonly occurring reducing sugars are crystalline, stable, insoluble bodies which can be easily separated from any attending impurities and identified by their melting points. Glucosazone melts at 205°, lactosazone at 200° and maltosazone at 206°.
The osazones are precipitated in the following way: The reducing sugar, in about ten per cent solution, is treated with an excess of the acetate of phenylhydrazin in acetic acid and warmed to from 75° to 85°. In a short time the separation is complete and the yellow precipitate formed is washed, dried and weighed. The sugar can be recovered from the osazone by decomposing it with strong hydrochloric acid by means of which the phenylhydrazin is displaced and a body, osone, is formed, which by treatment with zinc dust and acetic acid, is reduced to the [Pg 172] original sugar. The reactions which take place are represented by the following equations:[113]
For the complete precipitation of dextrose as osazone Lintner and Kröber show that the solution of dextrose should not contain more than one gram in 100 cubic centimeters. Twenty cubic centimeters containing 0.2 gram dextrose should be used for the precipitation.[114] To this solution should be added one gram of phenylhydrazin and one gram of fifty per cent acetic acid. The solution is then to be warmed for about two hours and the precipitate washed with from sixty to eighty cubic centimeters of hot water and dried for three hours at 105°. One part of the osazone is equivalent to one part of dextrose when maltose and dextrin are absent. When these are present the proportion is one part of osazone to 1.04 of dextrose. Where levulose is precipitated instead of dextrose 1.43 parts of the osazone are equal to one part of the sugar.
Sucrose is scarcely at all precipitated as osazone until inverted.
After inversion and precipitation as above, 1.33 parts osazone are equal to one part of sucrose.
The reaction with phenylhydrazin has not been much used for quantitive estimations of sugars, but it has been found especially useful in identifying and separating reducing sugars. It is altogether probable, however, that in the near future phenylhydrazin will become a common reagent for sugar work.
Maquenne has studied the action of phenylhydrazin on sugars and considers that this reaction offers the only known means of precipitating these bodies from solutions where they are found mixed with other substances.[115] The osazones, which are thus obtained, are usually very slightly soluble in the ordinary reagents, for which reason it is easy to obtain them pure when there is at the disposition of the analyst a sufficient quantity of the material. But if the sugar to be studied is rare and if it contain, moreover, several distinct reducing bodies, the task is more delicate. It is easy then to confound several osazones which have almost identical points of fusion; for example, glucosazone with [Pg 173] galactosazone. Finally, it becomes impossible by the employment of phenylhydrazin to distinguish glucose, dextrose or mannose from levulose alone or mixed with its isomers. Indeed, these three sugars give, with the acetate of phenylhydrazin the same phenylglucosazone which melts at about 205°. It is noticed that the weights of osazones which are precipitated when different sugars are heated for the same time with the same quantity of the phenylhydrazin, vary within extremely wide limits. It is constant for each kind of sugar if the conditions under which the precipitation is made are rigorously the same. There is then, in the weight of the osazones produced, a new characteristic of particular value. The following numbers have been obtained by heating for one hour at 100°, one gram of sugar with 100 cubic centimeters of water and five cubic centimeters of a solution containing forty grams of phenylhydrazin and forty grams of acetic acid per hundred. After cooling the liquid, the osazones are received upon a weighed filter, washed with 100 cubic centimeters of water, dried at 110° and weighed. The weights of osazones obtained are given in the following table:
| Character of the sugar. | Weight of the osazones. |
||
| gram. | |||
| Sorbine, | crystallized | 0.82 | |
| Levulose | ” | 0.70 | |
| Xylose | ” | 0.40 | |
| Glucose, | anhydrous | 0.32 | |
| Arabinose, | crystallized | 0.27 | |
| Galactose | ” | 0.23 | |
| Rhamnose | ” | 0.15 | |
| Lactose | ” | 0.11 | |
| Maltose | ” | 0.11 | |
With solutions twice as dilute as those above, the relative conditions are still more sensible, and the different sugars arrange themselves in the same order, with the exception of levulose, which shows a slight advantage over sorbine and acquires the first rank. From the above determinations, it is shown that levulose and sorbine give vastly greater quantities of osazones, under given conditions, than the other reducing sugars. It would be easy, therefore, to distinguish them by this reaction and to recognize their presence also even in very complex mixtures, where the polarimetric examination alone would furnish only uncertain indications. [Pg 174]
It is remarkable that these two sugars are the only ones among the isomers or the homologues of dextrose, actually known, which possess the functions of an acetone. They are not, however, easily confounded, since the glucosazone forms beautiful needles which are ordinarily visible to the naked eye, while the sorbinosazone is still oily and when heated never gives perfectly distinct crystals.
This method also enables us to distinguish between dextrose and galactose, of which the osazone is well crystallized and melts at almost the same temperature as the phenylglucosazone. Finally, it is observed that the reducing sugars give less of osazones than the sugars which are not capable of hydrolysis, and consequently differ in their inversion products. It is specially noticed in this study of the polyglucoses (bioses, trioses), that this new method of employing the phenylhydrazin appears very advantageous. It is sufficient to compare the weights of the osazones to that which is given under the same conditions by a known glucose, in order to have a very certain verification of the probabilities of the result of the chemical or optical examination of the mixture which is under study. All the polyglucoses which have been examined from this point of view give very decided results. The numbers which follow have reference to one gram of sugar completely inverted by dilute sulfuric acid, dissolved in 100 cubic centimeters of water, and treated with two grams of phenylhydrazin, the same quantity of acetic acid, and five grams of crystallized sodium acetate. All these solutions have been compared with the artificial mixtures and corresponding glucoses, with the same quantities of the same reagents. The following are the results of the examination:
| Character of the sugar. | Weight of the osazones. |
|
| gram. | ||
| 1 | Saccharose, ordinary | 0.71 |
| Glucose and levulose (.526 g each) | 0.73 | |
| 2 | Maltose | 0.55 |
| Glucose (1.052 g) | 0.58 | |
| 3 | Raffinose, crystallized | 0.48 |
| Levulose, glucose and galactose (.333 g each) | 0.53 | |
| 4 | Lactose, crystallized | 0.38 |
| Glucose and galactose (.500 g each) | 0.39 | |
It is noticed that the agreement for each saccharose is as satisfactory [Pg 175] as possible. Numbers obtained with the products of inversion are always a little low by reason of the destructive action of sulfuric acid, and in particular, upon levulose. This is, moreover, quite sensible when the product has to be heated for a long time with sulfuric acid in order to secure a complete inversion. It is evident from the data cited from the papers of Fischer, Maquenne, and others, that the determination of sugars by this method is not a very difficult analytical process and may, in the near future, become of great practical importance.
148. Molecular Weights of Carbohydrates.—In the examination of carbohydrates the determination of the molecular weights is often of the highest analytical value.
The uncertainty in respect of the true molecular weights of the carbohydrates is gradually disappearing by reason of the insight into the composition of these bodies, which recently discovered physical relations have permitted.
Raoult, many years ago,[116] proposed a method of determining molecular weights which is particularly applicable to carbohydrates soluble in water.
The principle of Raoult’s discovery may be stated as follows: The depression of the freezing point of a liquid, caused by the presence of a dissolved liquid or solid, is proportionate to the absolute amount of substance dissolved and inversely proportionate to its molecular weight.
The following formulas may be used in computing results:
C = observed depression of freezing point:
P = weight of anhydrous substance in 100 grams:
| C | = A = depression produced by one gram substance in 100 grams: |
| P |
K = depression produced by dissolving in 100 cubic centimeters a number of grams of the substance corresponding to its molecular weight:
M = molecular weight:
| Then we have, K = | C | × M. |
| P |
K is a quantity varying with the nature of the solvent but with the same solvent remaining sensibly constant for numerous groups of compounds. [Pg 176]
The value of
| A ( | C | ) |
| P |
can be determined by experiment. The molecular weight can therefore be calculated from the formula
| M = | K |
| A |
With organic compounds in water the value of K is almost constant.
Brown and Morris[117] report results of their work in extending Raoult’s investigations of the molecular weight of the carbohydrates. The process is carried on as follows:
A solution of the carbohydrate is prepared containing a known weight of the substance in 100 cubic centimeters of water. About 120 cubic centimeters of the solution are introduced into a thin beaker of about 400 capacity. This beaker is closed with a stopper with three holes. Through one of these a glass rod for stirring the solution is inserted. The second perforation carries a delicate thermometer graduated to 0°.05. The temperature is read with a telescope. The beaker is placed in a mixture of ice and brine at a temperature from 2° to 3° below the freezing point of the solution. The solution is cooled until its temperature is from 0°.5 to 1° below the point of congelation. Through the third aperture in the stopper a small lump of ice taken from a frozen portion of the same solution, is dropped, causing at once the freezing process to begin. The liquid is briskly stirred and as the congelation goes on the temperature rises and finally becomes constant. The reading is then taken. The depression in the freezing point, controlled by the strength of the solution, should never be more than from 1° to 2°.
The molecular weights may also be determined by the boiling points of their solutions as indicated by the author,[118] Beckmann,[119] Hite, Orndorff and Cameron.[120]
The method applied to some of the more important carbohydrates gave the following results:
149. Birotation.—As is well known, dextrose exhibits in fresh solutions the phenomenon of birotation. The authors supposed that this phenomenon might have some relation to the size of the molecule. They, therefore, determined the molecular volume of freshly dissolved dextrose by the method of Raoult and found M = 180. The high rotatory power of recently dissolved dextrose is therefore not due to any variation in the size of its molecule.
The mathematical theory of birotation is given by Müller as follows.[121] In proportion as the unstable modification A is transformed into the stable modification B, the rotation will vary. Let ρ = the specific rotatory power of B and aρ = that of A, both in the anhydrous state. Let now p grams of the substance be dissolved in V cubic centimeters of solvent and observed in a tube l decimeters in length. The time from making the solution is represented by θ. The angle of rotation α is read at the time θ. Let x = the mass of A, and y = that of B, and the equation is derived.
| α = | a ρ xl | + | ρyl |
| V | V |
But x + y = p
| whence α = [(a - 1)x + p] | ρl |
| V |
If now there be introduced into the calculation the final angle of rotation αn, which can be determined with great exactness; we have
| αn = | p ρ l |
| V |
| and consequently α = αn[1 + | (a - 1)x | ]. |
| p |
| whence | (a - 1)x | = | α | - 1. |
| p | αn |
[Pg 178] This equation gives the quantity x of the unstable matter which is transformed into the stable modification in the time θ.
It must be admitted that the quantity dx which is changed during the infinitely small time dθ is proportional to the mass x which still exists at the moment θ, whence dx = -Cʹxdθ where Cʹ represents a constant positive factor. From this is derived the equation
| dx | = - Cʹdθ. |
| x |
Integrating and calling x the quantity of matter changed to the stable form at the moment θ, corresponding to a rotation α₀, we have
| Cʹ = | 1 | log. nap. | x₀ | , |
| θ - θ₀ | x |
and taking into consideration the equation given above, and substituting common for superior logarithms we get
| C = | 1 | log. | α₀ - αₙ | . |
| θ - θ₀ | α - αₙ |
Experience has shown that such a constant C really exists, and its value can be easily calculated from the data of Parcus and Tollens.[122] The mean value of C from these data is 0.0301 for arabinose; 0.0201 for xylose; 0.0393 for rhamnose; 0.0202 for fucose; 0.00927 for galactose; 0.00405 for lactose; 0.00524 for maltose, and for dextrose, 0.00348 at 11° to 13° and 0.00398 from 13° to 15°. The constant C as is well known, increases as the temperature is raised.
The constant C, at a given temperature, measures the progress of the phenomenon of the change from the unstable to the stable state. It will be noticed that among the sugars possessing multirotation properties the pentoses possess a much higher speed of transformation than the others.
150. Estimation of Pentose Sugars and Pentosans as Furfurol.—The production of furfurol by distilling carbohydrates with an acid has already been mentioned. Tollens and his associates have shown that with pentose sugars, and carbohydrate bodies yielding them, the production of furfurol is quantitive. [Pg 179]
The production and estimation of furfurol have been systematically studied by Krug, to whose paper the reader is referred for the complete literature of the subject.[123] The essential principles of the operation are based on the conversion of the pentoses into furfurol by distilling with a strong acid, and the subsequent precipitation and estimation of the furfurol formed in the first part of the reaction.
The best method of conducting the distillation is as follows:
Five grams of the pentose substance are placed in a flask of about a quarter liter capacity, with 100 cubic centimeters of hydrochloric acid of 1.06 specific gravity. The arrangement of the apparatus is shown in Fig. 46. The flame of the lamp is so regulated as to secure about two cubic centimeters of distillate per minute.

Figure 46. Distilling Apparatus for Pentoses.
The distillate is received in a graduated cylinder and as soon as thirty cubic centimeters are collected, an equal quantity of hydrochloric acid, of the strength noted, is added to the distilling flask, allowing it to flow in slowly so as not to stop the ebullition. The process is continued until a drop of the distillate gives no sensible reaction for furfurol when tested with anilin acetate. The test is applied as follows: Place a drop of the distillate on a piece [Pg 180] of filter paper moistened with anilin acetate. The presence of furfurol will be disclosed by the production of a brilliant red color. Usually about three hours are consumed in the distillation, during which time a little less than 400 cubic centimeters of distillate is obtained. The distillate is neutralized with solid sodium carbonate and, in order to have always the same quantity of common salt present, 10.2 grams of sodium chlorid are added for each fifty cubic centimeters of water necessary to make the total volume to half a liter.[124]
The reactions with pentosans probably consist in first splitting up of the molecule into a pentose and the subsequent conversion of the latter into furfurol according to the following equations:
(C₅H₈O₄)ₙ + (H₂O)ₙ = (C₅H₁₀O₅)ₙ
Pentosan. Water.Pentose.
and
(C₅H₁₀O₅)ₙ = (C₅H₄O₂)ₙ + (3H₂O)ₙ.
Pentose. Furfurol.Water.
151. Determination of Furfurol.—The quantity of furfurol obtained by the process mentioned above may be determined in several ways.
As Furfuramid.—When ammonia is added to a saturated solution of furfurol, furfuramid, (C₅H₄O)₃N₂, is formed. In order to secure the precipitate it is necessary that the furfurol be highly concentrated and this can only be accomplished by a tedious fractional distillation. This method, therefore, has little practical value.
As Furfurolhydrazone.—Furfurol is precipitated almost quantitively, even from dilute solutions, by phenylhydrazin. The reaction is represented by the equation:
| C₆H₈N₂ | + | C₅H₄O₂ | = | C₁₁H₁₀N₂O | + | H₂O. |
| Phenylhydrazin. | Furfurol. | Furfurolhydrazone. | Water. |
152. Volumetric Methods.—Tollens and Günther have proposed a volumetric method which is carried out as follows:[125] The distillation is accomplished in the manner described. The distillate is placed in a large beaker, neutralized with sodium carbonate and acidified with a few drops of acetic. Phenylhydrazin solution of known strength is run in until a drop of the liquid, after thorough mixing, [Pg 181] shows no reaction for furfurol with anilin acetate. The reagent is prepared by dissolving five grams of pure phenylhydrazin and three of glacial acetic acid in distilled water, and diluting to 100 cubic centimeters. The solution is set by dissolving from two-tenths to three-tenths gram of pure furfurol in half a liter of water and titrating with the phenylhydrazin as indicated above. The quantity of the pentose used has a great influence on the result.
With nearly a gram of arabinose about fifty per cent of furfurol were obtained while when nearly five grams were used only about forty-six per cent of furfurol were found. With xylose a similar variation was found, the percentage of furfurol, decreasing as the quantity of pentose increased. The method, therefore, gives only approximately accurate results.
153. Method of Stone.—Another volumetric method proposed by Stone is based on the detection of an excess of phenylhydrazin by its reducing action on the fehling reagent.[126] A standard solution of phenylhydrazin is prepared by dissolving one gram of the hydrochlorate and three grams of sodium acetate in water and completing the volume of the liquor to 100 cubic centimeters. This solution contains 1.494 milligrams of phenylhydrazin in each cubic centimeter, theoretically equivalent to 1.328 milligrams of furfurol. The reagent is set by titrating against a known weight of furfurol. Pure furfurol may be prepared by treating the crude article with sulfuric acid and potassium dichromate, and subjecting the product to fractional distillation. The distillate is treated with ammonia and the furfuramid formed is purified by recrystallizing from alcohol and drying over sulfuric acid. One gram of this furfuramid is dissolved in dilute acetic acid and the volume completed to one liter with water.[127] The phenylhydrazin solution being unstable, is to be prepared at the time of use.
The titration is conducted as follows: Twenty-five cubic centimeters of the distillate obtained from a pentose body, by the method described above, are diluted with an equal volume of water, a certain quantity of the phenylhydrazin solution added to the mixture from a burette and the whole heated quickly to boiling. The flask is rapidly cooled and a portion of its contents poured on a filter. The filtrate should have a [Pg 182] pale yellow color and be perfectly clear. If it become turbid on standing, it should be refiltered. Two cubic centimeters of the clear filtrate are boiled with double the quantity of the fehling reagent. If phenylhydrazin be present, the color of the mixture will change from blue to green. By repeating the work, with varying quantities of phenylhydrazin, a point will soon be reached showing the end of the reaction in a manner entirely analogous to that observed in volumetric sugar analysis.
In practice the volumetric methods have given place to the more exact gravimetric methods described below.
154. Gravimetric Methods.—The distillation is carried on and the volume of the distillate completed to half a liter as described above. Chalmot and Tollens then proceed as follows:[128] Ten cubic centimeters of a solution of phenylhydrazin acetate, containing in 100 cubic centimeters twelve grams of the phenylhydrazin and seven and a half grams of glacial acetic acid dissolved and filtered, are added to the distillate and the mixture stirred with an appropriate mechanism for half an hour. The furfurolhydrazone at the end of this time will have separated as small reddish-brown crystals. The mixture is then thrown onto an asbestos filter and the liquid separated with suction. The suction should be very gradually applied so as not to clog the felt. The precipitate adhering to the beaker is washed into the filter with 100 cubic centimeters of water. The precipitate is dried at about 60° and weighed. As a check the hydrazone may be dissolved in hot alcohol, the filter well washed, dried and again weighed. To obtain the weight of furfurol the weight of hydrazone found is multiplied by 0.516 and 0.025 added to compensate for the amount which was held in solution or removed by washing. Less than one per cent of pentose can not be determined by this method since that amount is equalled by the known losses during the manipulation.
Factor.—To convert the furfurol found into pentoses, the following factors are used:
| Per cent furfurol obtained from five grams of pentoses. |
Multiply for arabinose by. |
Multiply for xylose by. |
Multiply for penta-glucoses by. |
| 2.5 per cent or less | 1.90 | 1.70 | 1.67 |
| 5.0 ” ” ” more | 2.04 | 1.90 | 1.92 |
[Pg 183] 155. Method Of Krug.—In conducting the determination of furfurol, according to the method of Chalmont and Tollens just noticed, Krug observed that the filtrate, after standing for some time, yielded a second precipitate of furfurol hydrazone. Great difficulty was also experienced in collecting the precipitate upon the filter on account of the persistency with which it stuck to the sides of the vessel in which the precipitation took place.[129] In order to avoid these two objections, Krug modified the method as described below and this modified method is now exclusively used in this laboratory.
After the precipitation of the furfurol hydrazone, it is stirred vigorously, by means of an appropriate mechanical stirrer, for at least half an hour and then allowed to rest for twenty-four hours. On filtering after that length of time the filtrate remains perfectly clear and no further precipitation takes place. After the filtration is complete and the beaker and filtering tube well washed, no attempt is made to detach the part of the filtrate adhering to the beaker but the whole of the precipitate, both that upon the filter and that adhering to the sides of the beaker, is dissolved in strong alcohol, from thirty to forty cubic centimeters being used. The alcoholic solution is collected in a small weighed flask, the alcohol evaporated at a gentle heat and the last traces of water removed by heating to 60° and blowing a current of dry air through the flask. After weighing the precipitate of furfurol hydrazone, obtained as above, the calculation of the weight of pentose bodies is accomplished by means of the usual factors.
156. Precipitation of Furfurol with Pyrogalol.—Furfurol is thrown out of solution in combination with certain phenol bodies by heating together in an acid solution. Hotter has proposed a method for the determination of furfurol based on the above fact.[130] The furfurol is obtained by distillation in the manner already described and hydrochloric acid is added if necessary to secure twelve per cent of that body in a given volume. The furfurol is thrown out of an aliquot portion by heating with an excess of pyrogalol in closed tubes for about two hours at 110°. The reaction takes place in two stages, represented by the following equations: [Pg 184]
C₅H₄O₂ + C₆H₆O₃ = C₁₁H₁₀O₅
and
2C₁₁H₁₀O₅ = C₂₂H₁₈O₉ + H₂O.
The aliquot part of the distillate used should not contain more than one-tenth of a gram of furfurol. The precipitate formed in this way is collected on an asbestos felt, dried at 103° and weighed. The weight obtained divided by 1.974 gives the corresponding amount of furfurol. There is some difficulty experienced in loosening the precipitate from the sides of the tubes in which the heating takes place, but this defect can be overcome by heating in covered beakers in an autoclave.
157. Precipitation with Phloroglucin.—Instead of using pyrogalol for the precipitating reagent phloroglucin may be employed. The method of procedure proposed by Councler for this purpose is given below.[131] The furfurol is prepared by distillation in the usual way. The volume of the distillate obtained is completed to half a liter with twelve per cent hydrochloric acid, and an aliquot portion, varying in volume with the percentage of furfurol is withdrawn for precipitation. This portion is placed in a glass-stoppered flask with about twice the quantity of finely powdered phloroglucin necessary to combine with the furfurol present. The contents of the flask are well shaken and allowed to stand fifteen hours. The precipitate is collected on an asbestos filter, washed free of chlorin, dried at the temperature of boiling water and weighed.
The theoretical quantity of precipitate corresponding to one part of furfurol, viz., 2.22 parts, is never obtained since the precipitate is not wholly insoluble in water. The actual proportions between the precipitate and the original furfurol vary with the amount of precipitate obtained.
When the weight of the precipitate is 200 milligrams and over, 2.12 parts correspond to one part of furfurol. When the weight of the precipitate varies from fifty to 100 milligrams, the ratio is as 2.05:1 and when only about twenty-five milligrams of precipitate are obtained the ratio is as 1.98:1.
The quantity of pentose bodies corresponding to the furfurol is calculated from the factors given by Tollens in a preceding paragraph. [Pg 185]
The reaction which takes place with furfurol and phloroglucin is simply a condensation of the reagents with the separation of water. It is very nearly represented by the following formula:
| 2C₅H₄O₂ | + | C₆H₆O₃ | = | C₁₆H₁₂O₆ | + | H₂O. |
| Furfurol. | Phloroglucin | Condensation product. |
Water. |
It has been shown by Welbel and Zeisel,[132] that in the presence of twelve per cent of hydrochloric acid phloroglucin itself is condensed into dark insoluble compounds. When three molecules of furfurol and two molecules of phloroglucin are present, the bodies are both condensed and separated by continued action. When from one and a quarter to three parts of phloroglucin by weight are used to one part of furfurol, the weight of the precipitate obtained under constant conditions may serve sufficiently well for the calculation of the furfurol. The precipitates contain chlorin, which they give up even in the cold, to water. For these reasons the analytical data obtained by the method of Councler, given above, are apt to be misleading. It is probable also that similar conditions may to a certain extent prevail in the separation of furfurol with phenylhydrazin, and further investigation in this direction is desirable. For the present the very best method that can be recommended for the estimation of pentoses and pentosans is the conversion thereof into furfurol and the separation of the compound with phenylhydrazin acetate.
158. Estimation of Sugars by Fermentation.—When a solution of a hexose sugar is subjected to the action of certain ferments a decomposition of the molecule takes place with the production of carbon dioxid and various alcohols and organic acids. Under the action of the ferment of yeast Saccharomyces cerevisiae the sugar yields theoretically only carbon dioxid and ethyl alcohol, as represented by the equation:
C₆H₁₂O₆ = 2C₂H₆O + 2CO₂.
The theoretical quantities of alcohol and carbon dioxid obtained according to this equation are 51.11 percent of alcohol and 48.89 per cent of carbon dioxid.
When the yeast ferment acts on cane sugar the latter first suffers inversion, and the molecules of dextrose and levulose produced are [Pg 186] subsequently converted into alcohol and carbon dioxid as represented below:
C₁₂H₂₂O₁₁ + H₂O = 2C₆H₁₂O₆
2C₆H₁₂O₆ = 4C₂H₆O + 4CO₂.
Cane sugar, plus the water of hydrolysis, will yield theoretically 53.8 per cent of alcohol and 51.5 per cent of carbon dioxid.
In practice the theoretical proportions of alcohol and carbon dioxid are not obtained because of the difficulty of excluding other fermentative action, resulting in the formation especially of succinic acid and glycerol. Moreover, a part of the sugar is consumed by the yeast cells to secure their proper growth and development. In all only about ninety-five per cent of the sugar can be safely assumed as entering into the production of alcohol. About 48.5 per cent of alcohol are all that may be expected of the weight of dextrose or invert sugar used. Only sugars containing three molecules of carbon or some multiple thereof are fermentable. Thus the trioses, hexoses, nonoses, etc., are susceptible of fermentation, while the tetroses, pentoses, etc., are not.
159. Estimating Alcohol.—In the determination of sugar by fermentation, a rather dilute solution not exceeding ten per cent should be used. A quantity of pure yeast, equivalent to four or five per cent of the sugar used, is added, and the contents of the vessel, after being well shaken, exposed to a temperature of from 25° to 30° until the fermentation has ceased, which will be usually in from twenty-four to thirty-six hours. The alcohol is then determined in the residue by the methods given hereafter.
The weight of the alcohol obtained multiplied by 100 and divided by 48.5, will give the weight of the hexose reducing sugar which has been fermented. Ninety-five parts of sucrose will give 100 parts of invert sugar.
Example.—Let the weight of alcohol obtained be 0.625 gram. Then 0.625 × 100 ÷ 48.5 = 1.289 grams, the weight of the hexose, which has been fermented; 1.289 grams of dextrose or levulose correspond to 1.225 of sucrose.
160. Estimating Carbon Dioxid.—The sugar may also be determined by estimating the amount of carbon dioxid produced during the [Pg 187] fermentation. For this purpose the mixture of sugar solution and yeast, prepared as above mentioned, is placed in a flask whose stopper carries two tubes, one of which introduces air free of carbon dioxid into the contents of the flask, and the other conducts the evolved carbon dioxid into the absorption bulbs. In passing to the absorption bulbs the carbon dioxid is freed of moisture by passing through another set of bulbs filled with strong sulfuric acid. During the fermentation, the carbon dioxid is forced through the bulbs by the pressure produced, or better, a slow current of air is aspirated through the whole apparatus. The aspiration is continued after the fermentation, has ceased, until all the carbon dioxid is expelled. Towards the end, the contents of the flask may be heated to near the boiling-point. The increase of the weight of the potash bulbs will give the weight of carbon dioxid obtained. A hexose reducing sugar will yield about 46.5 per cent of its weight of carbon dioxid. The calculation is made as suggested for the alcohol process.
The fermentation process has little practical value save in determining sucrose in presence of lactose, as will be described in another place.
161. Precipitation of Sugars in Combination with the Earthy Bases.—The sugars combine in varying proportions with the oxids and hydroxids of calcium, strontium and barium. Sucrose especially, furnishes definite crystalline aggregates with these bases in such a way as to form the groundwork of several technical processes in the separation of that substance from its normally and abnormally associated compounds. These processes have little use as analytical methods, but are of great value, as mentioned, from a technical point of view.
162. Barium Saccharate.—This compound is formed by mixing the aqueous solutions of barium hydroxid and sugar. The saccharate separates in bright crystalline plates or needles from the warm solution, as C₁₂H₂₂O₁₁BaO. One part of this precipitate is soluble in about forty-five parts of water, both at 15° and 100°.
163. Strontium Saccharates.—Both the mono- and distrontium saccharates are known, viz., C₁₂H₂₂O₁₁SrO + 5H₂O and C₁₂H₂₂O₁₁2SrO.
[Pg 188] The monosalt may be easily secured by adding a few of its crystals to a mixture of sugar and strontium hydroxid solutions.
The disaccharate is precipitated as a granular substance when from two to three molecules of strontium hydroxid are added to a boiling sugar solution. The reaction is extensively used in separating the sugar from beet molasses.
164. Calcium Saccharates.—Three calcium saccharates are known in which one molecule of sugar is combined with one, two and three molecules of lime respectively.
The monosaccharate is obtained by mixing the sugar and lime in the proper proportion and precipitating by adding alcohol.
The precipitate is partly granular and partly jelly-like, and is soluble in cold water. The dicalcium compound is obtained in the same way and has similar properties. Both, on boiling, with water, form the trisaccharate and free sugar.
The tricalcium saccharate is the most important of these compounds, and may be obtained directly by mixing freshly burned and finely ground lime (CaO) with a very cold dilute solution of sugar.
The compound crystallizes with three or four molecules of water. When precipitated as described above, however, it has a granular, nearly amorphous structure, and the process is frequently used in the separation of sugar from beet molasses.
In the laboratory but little success has been had in using even the barium hydroxid as a chemical reagent, and therefore the reactions mentioned above are of little value for analytical purposes. In separating sugar from vegetable fibers and seeds, however, the treatment with strontium hydroxid is especially valuable the sugar being subsequently recovered in a free state by breaking up the saccharate with carbon dioxid. The technical use of these reactions also is of great importance in the beet sugar industry.
165. Qualitive Tests for the Different Sugars.—The analyst will often be aided in examining an unknown substance by the application of qualitive tests, which will disclose to him the nature of the saccharine bodies with which he has to deal.
166. Optical Test for Sucrose.—The simplest test for the presence of sucrose is made with the polariscope. A small quantity of [Pg 189] the sample under examination is dissolved in water, clarified by any of the usual methods, best with alumina cream, and polarized. A portion of the liquor is diluted with one-tenth its volume of strong hydrochloric acid and heated to just 68°, consuming about fifteen minutes time in the operation. The mixture is quickly cooled and again polarized in a tube one-tenth longer than before used; or the same tube may be used and the observed reading of the scale increased by one-tenth. If sucrose be present the second reading will be much lower than the first, or may even be to the left.
167. Cobaltous Nitrate Test for Sucrose.—Sucrose in solution may be distinguished from other sugars by the amethyst violet color which it imparts to a solution of cobaltous nitrate. This reaction was first described by Reich, in 1856, but has only lately been worked out in detail. The test is applied as follows:
To about fifteen cubic centimeters of the sugar solution add five cubic centimeters of a five per cent solution of cobaltous nitrate. After thoroughly mixing the two solutions, add two cubic centimeters of a fifty per cent solution of sodium hydroxid. Pure sucrose gives by this treatment an amethyst violet color, which is permanent. Pure dextrose gives a turquoise blue color which soon passes into a light green. When the two sugars are mixed the coloration produced by the sucrose is the predominant one, and one part of sucrose in nine parts of dextrose can be distinguished. If the sucrose be mixed with impurities such as gum arabic or dextrin, they should be precipitated by alcohol or basic lead acetate, before the application of the test. Dextrin may be thrown out by treatment of the solution with barium hydroxid and ammoniacal lead acetate. The reaction may also be applied to the detection of cane sugar in wines, after they are thoroughly decolorized by means of lead acetate and bone-black. The presence of added sucrose to milk, either in the fresh or condensed state, may also be detected after the disturbing matters are thrown out with lead acetate. The presence of sucrose in honey may also be detected by this process. The reaction has been tried in this laboratory with very satisfactory results. The amethyst violet coloration with sucrose is practically permanent. On [Pg 190] boiling the color is made slightly bluish, but is restored to the original tint on cooling. Dextrose gives at first a fine blue color which in the course of two hours passes into a pale green. A slight flocculent precipitate is noticed in the tube containing the dextrose. Maltose and lactose act very much as dextrose, but in the end do not give so fine a green color. If the solutions containing dextrose, lactose and maltose be boiled, the original color is destroyed and a yellow-green color takes its place. The reaction is one which promises to be of considerable practical value to analysts, as it may be applied for the qualitive detection of sucrose in seeds and other vegetable products.[133]
168. The Dextrose Group.—In case the carbohydrate in question shows a right-handed rotation and the absence of sucrose is established by the polariscopic observation described above, the presence of the dextrose group may be determined by the following test.[134]
Five grams of the carbohydrate are oxidized by boiling with from twenty to thirty cubic centimeters of nitric acid of 1.15 specific gravity, and then at gentle heat evaporated to dryness with stirring. If much mucic acid be present, as will be the case if the original matter contained lactose some water is added and the mixture well stirred, and again evaporated to dryness to expel all nitric acid. The residue should be of a brown color. The mass is again mixed with a little water and the acid reaction neutralized by rubbing with fine-ground potassium carbonate. The carbonate should be added in slight excess and acetic acid added to the alkaline mixture, which is concentrated by evaporation and allowed to stand a few days. At the end of this time potassium saccharate has formed and is separated from the mother liquid by pouring on a porous porcelain plate. The residue is collected, dissolved in a little water and again allowed to crystallize, when it is collected on a porous plate, as before, and washed by means of an atomizer with a little aqueous spray until it is pure white and free of any oxalic acid. The residual acid potassium saccharate may be weighed after drying and then converted into the silver salt. The potash salt for this purpose is dissolved in water, neutralized with ammonia and precipitated with a solution of silver nitrate. The precipitate is well [Pg 191] stirred, collected on a gooch and washed and dried in a dark place. It contains 50.94 percent of silver. All sugars which contain the dextrose group yield silver saccharate when treated as above described. Inulin, sorbose, arabinose and galactose yield no saccharic acid under this treatment, and thus it is shown that they contain no dextrose group. Milk sugar, maltose, the dextrins, raffinose and sucrose yield saccharic acid when treated as above and therefore all contain the dextrose group.
169. Levulose.—The levulose group of sugars, wherever it occurs, when oxidized with nitric acid, gives rise to tartaric, racemic, glycolic and oxalic acids, which are not characteristic, being produced also by the oxidation of other carbohydrates. A more distinguishing test is afforded by the color reactions produced with resorcin.[135] The reagent is prepared by dissolving half a gram of resorcin in thirty cubic centimeters each of water and strong hydrochloric acid. To the sugar solution under examination an equal volume of strong hydrochloric acid is added, and then a few drops of the reagent. The mixture is gently warmed, and in the presence of levulose develops a fire-red color. Dextrose, lactose, mannose and the pentoses do not give the coloration, but it is produced by sorbose in a striking degree, and also by sucrose and raffinose since these sugars contain the levulose group.
170. Galactose.—The galactose which arises from the hydrolysis of milk sugar is readily recognized by the mucic acid which it gives on oxidation with nitric acid.[136] The analytical work is conducted as follows: The body containing galactose or galactan is placed in a beaker with about sixty cubic centimeters of nitric acid of 1.15 specific gravity for each five grams of the sample used. The beaker is placed on a steam-bath and heated, with frequent stirring, until two-thirds of the nitric acid have been evaporated. The residual mixture is allowed to stand over night and the following morning is treated with ten cubic centimeters of water, allowed to stand for twenty-four hours, filtered through a gooch, and the collected matter washed with twenty-five cubic centimeters of water, dried at 100° and weighed. The mucic acid collected in this way [Pg 192] will amount to about thirty-seven per cent of the milk sugar or seventy-five per cent of the galactose oxidized. Raffinose yields under similar treatment, about twenty-three per cent of mucic acid, which proves that the galactose group is contained in that sugar. Raffinose, therefore, is composed of one molecule each of dextrose, levulose, and galactose.
171. Invert Sugar.—The presence of a trace of invert sugar accompanying sucrose can be determined by Soldaini’s solution, paragraph 124, or by boiling with methyl blue.[137] Methyl blue is the hydrochlorate of an ammonium base, which, under the influence of a reducing agent, loses two atoms of hydrogen and becomes a colorless compound. The test for invert sugar is made as follows: The reagent is prepared by dissolving one gram of methyl blue in water. If the sugar solution is not clear, twenty grams of the sugar are dissolved in water clarified by lead subacetate, the volume completed to 100 cubic centimeters, and the solid matters separated by filtration. The filtrate is made slightly alkaline with sodium carbonate to remove the lead. A few drops of soda lye solution are then added and the mixture thrown on a filter. To twenty-five cubic centimeters of the filtrate a drop of the methyl blue solution is added, and a portion of the liquor heated in a test tube over the naked flame. If, after boiling for one minute, the coloration disappear, the sample contains at least 0.01 per cent of invert sugar; if the solution remain blue it contains none at all or less than 0.01 per cent. The test may also be made with the dilute copper carbonate solution of Ost described further on.
172. Compounds with Phenylhydrazin.—Many sugars may also be qualitively distinguished by the character of their compounds with phenylhydrazin. In general, it may be said that those sugars which reduce fehling solution form definite crystalline compounds with the reagent named. If a moderately dilute hot solution of a reducing sugar be brought into contact with phenylhydrazin acetate, a crystalline osazone is separated. The reaction takes place between one molecule of the sugar and two molecules of the hydrazin compound, according to the following formula:
C₆H₁₂O₆ + 2C₆H₅N₂H₃ = C₁₈H₂₂N₄O₄ + 2H₂O + H₂.
[Pg 193] The hydrogen does not escape but combines in the nascent state with the excess of phenylhydrazin to form anilin and ammonia.
The precipitation is accomplished as follows:
One part by weight of the sugar, two parts of phenylhydrazin hydrochlorate, and three parts of sodium acetate are dissolved in twenty parts of water and gradually heated on the water-bath.
The osazone slowly separates in a crystalline form and it is freed from the mother liquor by filtration, and purified by solution in alcohol and recrystallization. The crystals are composed of yellow needles, which are difficultly soluble in water and more easily in hot alcohol. The crystals are not decomposed by a dilute acid but are destroyed by the action of strong acids.
Dextrosazone.—The crystals melt at from 204° to 205°, reduce fehling liquor, and dissolved in glacial acetic acid are slightly left rotating.
Levulosazone.—This body has the same properties as the dextrose compound.
Maltosazone.—This substance melts at 206° with decomposition. It is left rotating. Its structure is represented by the formula C₂₄H₃₂N₄O₉.
Galactosazone.—This substance, C₁₈H₂₂N₄O₄, has the same centesimal composition as the corresponding bodies produced from dextrose and levulose. It is distinguished from these compounds, however, by its low melting point, viz., 193°.
The above comprise all the phenylosazones which are important from the present point of view. Sucrose, by inversion, furnishes a mixture of dextros- and levulosazones when treated with phenylhydrazin, while starch and dextrin yield the dextros- or maltosazone when hydrolyzed. Lactose yields a mixture of dextros- and galactosazones when hydrolyzed and treated as above described.
The reactions with phenylhydrazin are approximately quantitive and it is possible that methods of exact determination may be based on them in the near future.[138]
173. Other Qualitive Tests for Sugars.—The analyst may sometimes desire a more extended test of qualitive reactions than those [Pg 194] given above. The changes of color noticed on heating with alkalies may often be of advantage in discriminating between different sugars. The formation of definite compounds with the earthy and other mineral bases may also be used for qualitive determinations. One of the most delicate qualitive tests is found in the production of furfurol and this will be described in the following paragraphs.
174. Detection of Sugars and Other Carbohydrates by Means of Furfurol.—The production of furfurol (furfuraldehyd) as noted in paragraph 150, is also used quantitively for the determination of pentose sugars and pentosans.
Furfurol was first obtained from bran (furfur), whence its name, by treating this substance with sulfuric acid, diluted with three volumes of water, and subjecting the mixture to distillation. Its percentage composition is represented by the symbol C₅H₄O₂, and its characteristics as an aldehyd by the molecular structure C₄H₃O,C-HO.
Carbohydrates in general, when treated as described above for bran, yield furfurol, but only in a moderate quantity, with the exception of the pentoses.
Mylius has shown[139] that Pettenkofer’s reaction for choleic acid is due to the furfurol arising from the cane sugar employed, which, with the gall acid, produces the beautiful red-blue colors characteristic of the reaction.
Von Udránszky[140] describes methods for detecting traces of carbohydrates by the furfurol reaction, which admit of extreme delicacy. The solution of furfurol in water, at first proposed by Mylius, is to be used and it should not contain more than two and two-tenths per cent, while a solution containing five-tenths per cent furfurol is found to be most convenient. The furfurol, before using, should be purified by distillation, and, as a rule, only a single drop of the solution used for the color reaction.
The furfurol reaction proposed by Schiff[141] appears to be well suited for the detection of carbohydrates. It is made as follows:
Xylidin is mixed with an equal volume of glacial acetic acid and the solution treated with some alcohol. Strips of filter paper are then dipped in the solution and dried. When these strips of prepared paper are brought in contact with the most minute portion of furfurol, [Pg 195] furoxylidin is formed, C₄H₃OCH(C₈H₈NH₂)₂, producing a beautiful red color. In practice, a small portion of the substance, supposed to contain a carbohydrate, is placed in a test tube and heated with a slight excess of concentrated sulfuric acid. The prepared paper is then placed over the mouth of the test tube so as to be brought into contact with the escaping vapors of furfurol.
The furfurol reaction with α-naphthol for some purposes, especially the detection of sugar in urine, is more delicate than the one just described. This reaction was first described by Molisch[142], who, however, did not understand its real nature.
The process is carried on as follows: The dilute solution should contain not to exceed from 0.05 to one-tenth per cent of carbohydrates. If stronger, it should be diluted. Place one drop of the liquid in a test tube with two drops of fifteen per cent alcoholic solution of α-naphthol, add carefully one-half cubic centimeter of concentrated sulfuric acid, allowing it to flow under the mixture. The appearance of a violet ring over a greenish fringe indicates the presence of a carbohydrate. If the substance under examination contain more than a trace of nitrogenous matter, this must be removed before the tests above described are applied.
If the liquids be mixed by shaking when the violet ring is seen, a carmine tint with a trace of blue is produced. If this be examined with a spectroscope, a small absorption band will be found between D and E, and from F outward the whole spectrum will be observed. One drop of dextrose solution containing 0.05 per cent of sugar gives a distinct reaction by this process. It can be used, therefore, to detect the presence of as little as 0.028 milligram of grape sugar. This test has been found exceedingly delicate in this laboratory, and sufficiently satisfactory without the spectroscopic adjunct.
The furfurol reaction is useful in detecting the presence of minute traces of carbohydrates but is of little value in discriminating between the different classes of these bodies.
It is not practical here to go into greater detail in the description of qualitive reactions. The analyst, desiring further information, should consult the standard works on sugar chemistry. [143]
[Pg 196] 175. Detection of Sugars by Bacterial Action.—Many forms of bacteria manifest a selective action towards sugars and this property may in the future become the basis of a qualitive and even quantitive test for sugars and other carbohydrates. Our present knowledge of the subject is due almost exclusively to the researches of Smith, conducted at the Department of Agriculture.[144] Dextrose is the sugar first and most vigorously attacked by bacterial action, and by proper precautions the whole of the dextrose may be removed from mixtures with sucrose and lactose.
The development of other forms of micro-organisms which will have the faculty of attacking other and special forms of carbohydrates is to be looked for with confident assurance of success.
176. Constitution of Starch.—The molecule of starch is without doubt formed by the condensation of a large number of hexose bodies. On account of its great insolubility its molecular weight has not been determined with any degree of accuracy. Its formula may be expressed either as (C₆H₁₀O₅)ₙ or (C₁₂H₂₀O₁₀)ₙ. It is insoluble in cold water and other common solvents and does not pass into solution in any reagent without undergoing a change of structure. In hot water it forms a paste and when heated under pressure with water it undergoes a partial change and becomes soluble. Heated with acids or subjected to the action of certain ferments it suffers hydrolysis and is transformed into dextrin, maltose and dextrose. In analytical work an attempt is usually made to transform the starch entirely into dextrose, the quantity of which is then determined by some of the processes already given. All starches possess the property of giving an intensely blue color with iodin and this reaction serves to detect the most minute quantity of the material.
Starch grains derived from different sources are distinguished by differences in size and appearance. In most cases a careful examination of the starch particles will reveal their origin.[145] The greatest part of the cereal grains is composed of starch, the percentage ranging from sixty to eighty. Rice has the greatest [Pg 197] percentage of starch in its composition of any substance. Certain root crops are also rich in starch, such as the potato, artichoke and cassava. Starch appears as one of the first products of vegetable metabolism, according to some authorities, preceding the formation of sugars. By reason of its greater complexity, however, it is more probable that the production of simple sugars precedes the formation of the more complex molecule. Starch granules are probably used as a food by the plant in the building of more complex structures and the excess of this food is stored in the seeds and in tubers.
177. Separation of Starch Particles.—Advantage is taken of the insolubility of the starch particles to secure their separation from the other vegetable structures with which they are associated. The substances containing starch are reduced to a pulp as fine as possible, and this pulp being placed in a fine cloth the starch particles are washed through the cloth with water. The milky filtrate carrying the starch is collected in an appropriate holder and, after some time, the particles subside. They may then be collected and dried. While this process is the one used commercially in the manufacture of starch, it can only give approximate data respecting the actual quantity of starch in a given weight of the sample. It is not quite possible by this method to get all the starch separated from the rest of the vegetable matter, and particles of foreign substances, such as cellulose and albuminoid matters, may pass through the filter cloth and be found with the deposited granules. It follows from this that the quantitive determination of the starch in a given sample by any direct method is only approximately exact.
178. Methods of Separation.—Hot acids cannot be safely employed to dissolve starch from its natural concomitants because other carbohydrate bodies become soluble under similar conditions. In such cases the natural sugars which are present should be removed by cold water and the starch dissolved from the residue by a diastatic ferment. Instead of this the sugars may be determined in a separate portion of the pulped material and the starch, together with the sugars, determined, and the quantity of sugar found deducted from the final result. [Pg 198]
In these cases the final determinations are made on the sugars, after inverting the sucrose, and proceeding as directed for invert sugars in paragraph 141. The starch, after separation with diastase, is converted into dextrose by one of the methods to be given and the resulting dextrose determined by one of the approved methods.
179. Separation with Diastase.—Diastase or malt extract at a temperature of about 65° rapidly renders starch soluble. Cereals, potato meal and other starch-holding bodies are dried, first at a low temperature, and extracted with ether or petroleum to remove fat. The material is then rubbed up with water, boiled, cooled to 65°, and treated with malt extract (diastase) prepared as given below. One kilogram of ground green malt is mixed with one liter of glycerol and an equal quantity of water, and allowed to stand, with frequent shaking, for eight days. After that time the mixture is filtered, first through a small filter press and afterwards through paper. In case no filter press is at hand the mixture may be pressed in a bag and the liquor obtained, filtered. Malt extract obtained in this way will keep its diastatic properties for a long time. In its use, blank determinations must be made of the dextrose produced by treating equal portions of it with hydrochloric acid. For three grams of starchy material twenty-five cubic centimeters of the malt solution should be used and the mixture kept at 65° for two hours.[146]
180. Method in Use at the Halle Station.—The method of separating starch from cereals, potatoes and other starch-holding materials, employed at the Halle station, is essentially the same as already described.[147]
The malt extract used is prepared immediately beforehand, inasmuch as no preservative is added to it. It can be quickly prepared by digesting, for a short time at not above 50°, 100 grams of finely ground dried malt with one liter of water and separating the extract by filtration. This extract will keep only a few hours.
The material in which the starch is to be determined is dried and extracted with ether. From two to four grams of the extracted material, [Pg 199] according to the amount of starch which it contains, are boiled for half an hour with 100 cubic centimeters of water, cooled to 65°, treated with ten cubic centimeters of malt extract and kept at the temperature named for half an hour. It is then again boiled for fifteen minutes, cooled to the temperature mentioned and again treated with malt extract as above. Two treatments with malt extract are usually sufficient to bring all the starch into solution. Finally it is again boiled and the volume completed to 250 cubic centimeters and thrown upon a filter. Two hundred cubic centimeters of the filtrate are converted into dextrose by boiling with hydrochloric acid, and the rest of the analysis is conducted in the usual manner. The dextrose value of the quantity of malt extract used must be determined upon a separate portion thereof, and the quantity of dextrose found deducted from the total amount obtained in the analysis.

Figure 47.
Autoclave for
Starch Analysis.
181. Separation by Hydrolysis with Water at High Temperatures.—Instead of dissolving the starch with diastase, it may be brought into solution by heating with water under pressure. The former method employed of heating in sealed flasks has been entirely superceded by heating in an autoclave. The materials are best held in metal beakers furnished with a cover which prevents loss from boiling if the pressure should be removed too rapidly after the completion of the operation. The autoclave is a strong metal vessel capable of resisting the pressure of several atmospheres. It is furnished with a pressure gauge C and a safety valve D, as shown in the figure. The top is securely screwed on by means of a wrench, shown at the right hand [Pg 200] side. In the figure a portion of the case is represented cut away to show the arrangement of the metal beakers inside.
In the method of Reinke, as practiced at the Halle station, and in this laboratory, about three grams of the starchy substance are placed in each of the metal beakers with twenty-five cubic centimeters of a one per cent lactic acid solution and thirty cubic centimeters of water. The contents of the beaker are thoroughly mixed and they are then heated for two and a half hours in the autoclave, at a pressure of three and a half atmospheres. The addition of the lactic acid is for the purpose of protecting any sugar which may be present from decomposition at the high pressure and temperature employed. After the completion of the heating, the autoclave is allowed to cool, the cover is removed and the beakers taken out and their contents washed with hot water into quarter liter flasks. After cooling, the volume is completed with cold water, and after standing for half an hour, with frequent shaking, the contents of the flasks are filtered and 200 cubic centimeters of the filtrate in each case converted into dextrose with hydrochloric acid in the usual way. In order to obtain agreeing results, it is highly necessary that the substance before treatment should be ground to a fine powder. The addition of the lactic acid, as practiced in the reinke method, tends to give somewhat high results, due probably to the hydrolytic action of the acid on the fiber present. When starchy bodies are heated in the autoclave for the determination of their starch by polarimetric methods, or for ordinary determinations, the use of lactic acid should be omitted.
Example.—The following data indicate the methods of calculation to be followed in the determination of the percentage of starch in the material by diastatic hydrolysis: Three grams of a barley were inverted by diastase, as directed above, the volume of the solution made a quarter of a liter, filtered, 200 cubic centimeters of the filtrate converted into dextrose by hydrochloric acid, the volume completed to half a liter with water and fifty cubic centimeters thereof oxidized by the alkaline copper solution in the usual way. The amount of copper obtained was 331 milligrams, corresponding to 174 milligrams of dextrose. The amount of malt extract used in hydrolyzing the barley [Pg 201] mentioned above, was ten cubic centimeters. The diastatic solution inverted with hydrochloric acid and treated as indicated above, yielded 191 milligrams of copper, corresponding to ninety-eight milligrams of dextrose in ten cubic centimeters of the malt extract. The quantity of malt extract represented in the final determination of copper, however, was only one and six-tenths cubic centimeters. We then have:
| Total dextrose | 174 | milligrams |
| Dextrose in one and six-tenths cubic centimeters | ||
| malt extract | 16 | milligrams |
| Dextrose corresponding to 240 milligrams | ||
| of barley | 158 | milligrams |
Calculated on the proportion that dextrose is to starch, as ten is to nine, this is equivalent to 142 milligrams of starch. The percentage of starch in the original substance, therefore, was equivalent to 142 multiplied by 100, divided by 240, viz., 59.17.
182. Principles of the Methods of Determination.—In the approximately pure state in which starch exists in the trade, it may be determined by conversion into dextrose and estimating the latter by one of the methods given. It is probable that there is no known method by which starch can be entirely converted into dextrose, and all the methods of hydrolysis, when used for quantitive purposes, must be standardized, not by the theoretical quantity of dextrose which a given weight of pure starch should yield, but by the actual quantity obtained. Starch is not largely converted into dextrose by any of the diastatic ferments which produce principally maltose and dextrins. Recourse must therefore be had to strong acids. In practice, hydrochloric is the one usually employed. By the action of a hot mineral acid, not only is starch converted into dextrose, but also the dextrose found is subjected to changes. In such cases an opposing action seems to be exerted by the hydrolytic agent, a part of the dextrose formed suffering a partial condensation, and thus assuming a state of higher molecular weight, approaching the constitution of the dextrins. Another part of the dextrose may also suffer oxidation and thus disappear entirely in respect of the further steps in starch analysis. [Pg 202]
In such cases, the best the analyst can do is to conduct the hydrolysis in as nearly as possible constant conditions, and to assume that the percentage of dextrose present at a given time bears a constant ratio to the quantity of starch hydrolyzed. In reality almost all the starch appears finally as dextrose, and by proceeding on the assumption noted above a fairly satisfactory accounting may be made of the remainder.
Starch being insoluble, it cannot be determined directly by its rotatory power. When heated for a few hours in contact with water at a high pressure, starch becomes soluble, and in this state has a fairly constant gyrodynat, viz., [a]D = 197°.
Starch is also rendered soluble by rubbing it in a mortar for about ten minutes with an excess of strong hydrochloric acid, and in this way a quick approximate idea may be obtained of the percentage present. Starch prepared in this manner, however, has a strong reducing power on metallic salts, showing that a part of it has already, even in so short a time, assumed the state of maltose or dextrose. The gyrodynat of pure anhydrous starch in such conditions varies from [a]D = 197° to [a]D = 194°. Starch is also rendered soluble by boiling with salicylic acid, whereby a solution is obtained having a gyrodynat of [a]D = 200°(circa). The methods of procedure for the analysis of starch will be set forth in detail in the following paragraphs.
183. Estimation of Water.—In prepared or commercial starches the water may be determined by heating in a partial vacuum. The temperature at first should be low, not exceeding 60°. After drying for an hour at that heat the temperature may be gradually increased. The last traces of water come off from starch with difficulty, and the final temperature may be carried a little beyond 100° without danger of decomposition.
Ost recommends the use of an atmosphere of hydrogen or illuminating gas.[148] One and a half grams of the finely powdered sample are placed in the drying tube described in paragraph 23, and heated in a stream of dry hydrogen. The temperature at first is kept at about 60° for several hours and is then gradually increased to 120°. Ost states that even at 150° the sample preserves its pure white color, but so high a temperature is not necessary. Maercker, at the Halle station, [Pg 203] makes use of the same process, but employs illuminating gas instead of hydrogen. The importance of beginning the desiccation at a low temperature arises from the fact that at a higher temperature, before the greater part of the water is driven off, the starch will suffer a partial fusion and form a paste which is very difficult to dry. The dried sample must be kept in a stoppered vessel to prevent the absorption of hygroscopic moisture.
184. Estimation of Ash.—When the drying is accomplished in a flat platinum dish, the same sample may serve for incineration. Otherwise the incineration may be accomplished in another portion of the sample by following directions already given.[149]
185. Nitrogen.—Even very pure samples of starch may contain a little nitrogen which is most conveniently determined by moist combustion.[150]
As a rule, in commercial starches of good quality, the quantity of pure starch may be considered to be the remainder after subtracting the sum of the weights of water, ash and nitrogen multiplied by 6.25, from the original weight of the sample taken.
| Example:— | ||
| Per cent of | moisture found | 12.85 |
| ” ” ” | ash found | 0.08 |
| ” ” ” | nitrogen × 6.25 | 0.27 |
| Sum | 13.20 | |
| Per cent of | pure starch in sample | 86.80 |
Samples of starch usually contain also traces of fat and fiber, and these when present in weighable quantities, should be determined and proper deductions made.
186. Hydrolysis with Acids.—The acids commonly chosen for hydrolyzing starch are sulfuric and hydrochloric. The former has the advantage of being more easily removed from the finished product but the latter performs the work with less damage to the sugars formed. For commercial purposes sulfuric and for analytical practice hydrochloric acids are commonly employed. [Pg 204]

Figure 47 (bis). Maercker’s
Hydrolyzing Apparatus for Starch.
The best process for analytical purposes is the one proposed by Sachsse.[151] In this method the starch is heated with the hydrolyzing mixture in the proportion of three grams to 200 cubic centimeters of water and twenty of hydrochloric acid of 1.125 specific gravity, containing five and six-tenths grams of the pure gas. The heating is continued for three hours on a steam-bath. Maercker recommends, instead of the above procedure, heating for two hours at gentle ebullition in an oil-bath. In this method three grams of the starch are reduced to paste with 200 cubic centimeters of water, and then boiled for two hours with fifteen [Pg 205] cubic centimeters of hydrochloric acid of 1.125 specific gravity. The erlenmeyers in which the hydrolysis takes place are heated in an oil-bath and are provided with reflux condensers made of long glass tubes on which some bulbs have been blown, as shown in the accompanying figure. In all cases after hydrolysis the solution is neutralized, made to a standard volume and an aliquot part, after filtration, diluted to contain an amount of dextrose suited to the use of the table by Allihn for calculating the percentage of sugar. In diluting the solution preparatory to the estimation of dextrose, it is well to remember that nine parts of starch will furnish theoretically ten parts of dextrose. Since three grams of the sample are used, containing approximately eighty-five per cent of starch, the quantity of dextrose present is a little less than three grams. The solution should therefore contain not less than 300 cubic centimeters.
187. Factor for Calculating Starch from the Dextrose Obtained.—If all the starch could be converted into dextrose without loss, the quantity of it could be easily calculated theoretically on the supposition that the formula of starch is (C₆H₁₀O₅)ₙ. The factor by this assumption is, starch = dextrose × 0.90. If the starch have the formula assigned to it by Nägeli, viz., C₃₆H₆₂O₃₁ the formula becomes, starch = dextrose × 0.918.
Ost prefers to work by Sachsse’s method and to use the factor 0.925 to convert the dextrose into starch.[152]
In view of all the facts in the case it appears that the analyst will reach nearly correct results by converting the starch into dextrose by heating for three hours at 100° with hydrochloric acid or for two hours at gentle ebullition as directed above, determining the resultant dextrose and multiplying the weight thereof by 0.92.
188. Polarization of Starch.—Starch may be prepared for polarization by dissolving it in cold hydrochloric acid. The process as carried out by Effront is as follows.[153] Five grams of starch are rubbed with twenty cubic centimeters of cold concentrated hydrochloric acid for nearly ten minutes or until the solution is quite clear. The volume is completed to 200 cubic centimeters with water and the solution polarized. By this process there is always produced a notable quantity of reducing sugars, and for [Pg 206] this reason it must be admitted that a portion of the starch has suffered complete hydrolysis. Ost therefore recommends the use of an acid of 1.17 specific gravity, and the gyrodynat of the soluble starch thus produced is found to vary from [a]D = 196°.3 to 196°.7. When acid of 1.20 specific gravity is employed the gyrodynat falls to [a]D = 194.2.[154] For approximately correct work the solution with the weaker hydrochloric acid and subsequent polarization is to be recommended as the most rapid method for starch determination.
It will be of interest to add the observation that the gyrodynat of maltose has lately been redetermined by Ost, who finds it to be [a]D²⁰ ° = 137°.04 ± 0.19.[155]
189. Solutions of Starch at High Pressure.—Starch may also be brought into a condition suited to polarization by dissolving in water at a high temperature and pressure. The solution is accomplished in an autoclave as described in 181.
From two to three grams of starch are used and from eighty to ninety cubic centimeters of water. The starch is first reduced to a pasty state by heating with the water and, when evenly distributed throughout the flask, is rendered soluble by heating from three to five hours in an autoclave at from two to three atmospheres. The material is entirely without action on an alkaline copper solution. After heating, the volume of the solution is completed to 100 cubic centimeters and it is then polarized. The gyrodynat of starch dissolved in this way varies from [a]D = 196°.5 to 197°.[156]
Starch is prepared by Baudry for polarization by boiling with salicylic acid.[157] The gyrodynat of starch dissolved in this way is [a]D = 200°.25.
190. Polarization after Solution in Dilute Nitric Acid.—Guichard recommends saccharification with ten per cent nitric acid (ten cubic centimeters strong acid, ninety cubic centimeters water).[158] This treatment, even after prolonged boiling, gives only a light straw color to the solution which does not interfere with its polarization with a laurent instrument.
In working on cereals four grams of the finely ground material, in which the bran and flour are intimately mixed, are used.
The material is placed in a flask of about 500 cubic centimeters [Pg 207] capacity, with 100 cubic centimeters of the dilute acid. The flask is closed with a stopper carrying a reflux condenser. After boiling for an hour the contents of the flask are filtered and examined in the saccharimeter. The dextrose formed is determined by the polarimetric data and the quantity of starch transformed calculated from the dextrose. The following formula is used:
| A = | av × 25 × 0.016 |
| 2 × 52.8 |
In this formula a = the rotation in angular degrees, v = the volume of the liquid and A = the starch transformed.
In this method no account is taken of the sucrose and other sugars which are present in cereals. In the case of sucrose the left-handed sugar produced by treatment with nitric acid would diminish the rotation to the right and thus introduce an error. On the other hand the dextrose formed from the fiber of the bran would be calculated as starch. If these two errors should be compensating the method might prove practical.
191. Rapid Estimation Of Starch.—For the rapid estimation of starch in cereals, cattle foods and brewery refuse, Hibbard recommends a method which is carried out as follows:
The malt extract is prepared by covering ground, dry malt with water containing from fifteen to twenty per cent of alcohol. The object of adding alcohol is to preserve the filtered extract. It exercises a slight retarding effect on the action of the diastase, but prevents the malt extract from fermenting. After standing for a few hours in contact with the malt, the liquid is separated by filtration and is then ready for use. The substance in which the starch is to be determined should be dry enough to be finely pulverized, but previous extraction with ether is omitted. Enough of the material to contain at least half a gram of starch is placed in a flask with fifty cubic centimeters of water and from one to two cubic centimeters of malt extract added. The mixture is at once heated to boiling with frequent shaking to prevent the formation of clots. The addition of the diastase before boiling is to aid in preventing the formation of lumps. After boiling a minute the mixture is cooled to 60° and from two to three cubic centimeters of the malt extract added. It is then slowly heated until it again boils, [Pg 208] consuming about fifteen minutes, when, after cooling, it is tested with iodin for starch. If a blue color be produced the operation above described is repeated until it fails to reappear. The mixture is then made up to a standard volume, thrown on a linen filter and an aliquot part of the filtrate, representing from 200 to 300 milligrams of starch, is boiled with five cubic centimeters of hydrochloric acid, of thirty per cent strength, for half an hour. The total volume of the liquid before boiling should be completed to sixty cubic centimeters. By the method above described, it is claimed that the determination of starch in a cereal or similar substance can be completed within two hours. The chief amount of time saved is in the heating with the malt extract, which instead of being continued for two hours, as usually directed, can be accomplished in thirty minutes.[159]
192. Precipitation of Starch with Barium Hydroxid.—The tendency of carbohydrate bodies to unite with the earthy bases has been utilized by Asboth as a basis for the quantitive determination of starch.[160]
About three grams of the finely ground sample containing the starch, or one gram of pure starch, are rubbed up in a mortar with water and the detached starch remaining suspended in the wash water is poured off. This operation is repeated until all the starch is removed. In difficult cases hot water may be used. The starch thus separated is heated in a quarter liter flask to the boiling point to reduce it to the condition of paste. When the paste is cold it is treated with fifty cubic centimeters of the barium hydroxid solution, the flask closed and well shaken for two minutes. The volume is then completed to the mark with forty-five per cent alcohol, the flask well shaken and allowed to stand. In a short time the barium-starch compound separates and settles. Fifty cubic centimeters of the clear supernatant liquor are removed with a pipette, or the liquor may be passed through a filter and the quantity mentioned removed for titration of the residual barium hydroxid after the addition of a few drops of phenolphthalein solution.
The quantity of barium hydroxid remaining, deducted from the original quantity, gives the amount which has entered into composition with the [Pg 209] starch; the composition of the molecule being BaOC₂₄H₄₀O₂₀, which contains 19.10 per cent of barium oxid and 80.90 per cent of starch.
The set solution of barium hydroxid must be preserved from contact with the carbon dioxid of the air. The burette should be directly attached to the bottle holding the set solution, by any of the usual appliances, and the air entering the bottle must be deprived of carbon dioxid. The water used in the work must be also free of air, and this is secured by boiling immediately before use.
Example.—A sample of flour selected for the analysis weighed 3.212 grams. The starch was separated and reduced to paste in the manner described above. Thirty and four-tenths cubic centimeters of tenth-normal hydrochloric acid were exactly neutralized by ten cubic centimeters of the barium hydroxid solution. After treatment as above described, fifty cubic centimeters of the clear liquor, corresponding to ten cubic centimeters of the added barium hydroxid, required 19.05 cubic centimeters of tenth-normal hydrochloric acid. Then 30.4 - 19.05 = 11.35, and 11.35 x 5 = 56.75, which number corresponds to the total titration of the residual barium hydroxid in terms of tenth-normal hydrochloric acid. This number multiplied by 0.0324, viz., starch corresponding to one equivalent of barium, gave 1.8387 grams of starch or 57.24 per cent of the weight of flour employed.
The barium hydroxid method has been given a thorough trial in this laboratory and the results have been unsatisfactory when applied to cereals. The principle of the process, however, appears to be sound, and with a proper variation of working details, it may become practical.
193. Disturbing Bodies in Starch Determinations.—Stone has made a comparison of the standard methods of starch determinations, and the results of his work show that in the case of pure starch all of the standard methods give approximately correct figures. For instance, in the case of a pure potato starch, the following data were obtained:
By inversion with hydrochloric acid, 85.75 per cent; by inversion with oxalic and nitric acids, 85.75 per cent; by solution in salicylic acid, 85.47 per cent; and by precipitation with barium hydroxid, 85.58 per cent.[161]
[Pg 210] When these methods are used, however, for the determination of starch in its original state, the widest variations are secured. Stone shows that these variations are due chiefly to the inverting effect of the reagents employed upon the pentosans present. In experiments made with pure xylan obtained from wheat straw, the methods employed gave from 44.73 to 67.16 per cent of material, which would be calculated by the usual methods as starch. Stone also shows that the pentosans are practically unaffected by the action of diastase or malt extract. Pure xylan treated with diastase, under the condition in which starch is converted into maltose and other soluble carbohydrates, fails to give any subsequent reaction whatever with alkaline copper solution. In all cases, therefore, where starch occurs in conjunction with pentose bodies, it is necessary to separate it by diastatic action before applying any of the methods of conversion of the starch into dextrose or its precipitation by barium hydroxid.
194. Colorimetric Estimation of Starch.—The production of the intensely blue color which starch gives with iodin has been used not only as the basis of a qualitive method, but also of many attempts at quantitive determination. These attempts have, as a rule, been attended with very unsatisfactory results, due both to the extraordinary delicacy of the reaction and to the fact that starches of different origin do not always give exactly the same intensity of tint when present in the same quantity. At the present it must be admitted that little should be expected of any quantitive colorimetric test.
In case such a test is desired the procedure described by Dennstedt and Voigtländer may be followed.[162] A weighed quantity of the starch-holding material, containing approximately half a gram of starch, is placed in a two liter flask and boiled with a liter of water. After cooling, the volume is completed to two liters and the starch allowed to subside. Five cubic centimeters of the clear supernatant liquor are placed in a graduated cylinder holding 100, and marked in half cubic centimeters. One drop of a solution of iodin in potassium iodid is added and the volume completed to the mark. A half gram of pure starch is treated in the same way and different [Pg 211] measured portions of the solution treated as above until the color of the first cylinder is matched. From the quantity of pure starch in the matched cylinder the quantity in the sample is determined. The test should be made in duplicate or triplicate. If a violet color be produced instead of a blue, it may be remedied by treating the sample with alcohol before the starch granules are dissolved.
195. Fixation of Iodin.—In addition to forming a distinctive blue color with iodin, starches have the power of fixing considerable quantities of that substance. The starches of the cereals have this power in a higher degree than those derived from potatoes. In presence of a large excess of iodin the starches of rice and wheat have a maximum iodin-fixing power of about nineteen per cent of their weight. When only enough of iodin is employed to enter into combination the percentage absorbed varies from nine to fifteen per cent. The absorption of iodin by starches is a matter of importance from a general chemical standpoint, but as at present determined has but little analytical value. It is evident, however, that this absorption must take place according to definite chemical quantities and the researches of investigators may in the future discover some definite quantitive method of measuring it.[163]
196. Identification of Starches of Different Origin.—It is often important, especially in cases of suspected adulteration, to determine the origin of the starch granules. For this purpose the microscope is the sole resort. In many cases it is easy to determine the origin of the starch by the size or the shape and marking of the grains. In mixtures of more than one kind of starch the distinguishing features of the several starches can be clearly made out in most instances. There are, however, many instances where it is impossible to discriminate by reason of the fact that the characteristics of starch granules vary even in the same substance and from year to year with varying conditions of culture.
In many cases the illustrations of the forms and characteristics of starch granules which are found in books are misleading and no reliance can be placed on any illustrations which are not either photographs or drawings made directly from them. In the microscopic study of starches [Pg 212] the analyst will be greatly helped by the following descriptions of the characteristic appearance of the granules and the classifications based thereon.[164]
197. Vogel’s Table of the Different Starches and Arrowroots of Commerce.—A. Granules simple, bounded by rounded surfaces.
B. Granules simple or compound, single granules or parts of granules, either bounded entirely by plain surfaces, many-angled, or by partly round surfaces. [Pg 213]
C. Granules simple and compound; predominant forms, oval, with eccentric nucleus and numerous layers; the compound granule made up of a large granule and one or more relatively small kettledrum-shaped ones; 0.025-0.066 mm, sago starch. [Pg 214]
198. Muter’s Table for the Detection of Starches
when Magnified about 230 Diameters.
[All measurements are given in decimals of an inch.]
Group I: All more or less oval in shape and having both hilum and rings visible.
| Name. | Shape. | Normal measurements. |
Remarks. |
|---|---|---|---|
| Tous les mois | Oval, with flat ends | 0.00370 to 0.00185 |
Hilum annular, near one end and incomplete rings. |
| Potato | Oval | 0.00270 to 0.00148 |
Hilum annular, rings incomplete, shape and size very variable. |
| Bermuda arrowroot |
Sack-shaped | 0.00148 to 0.00129 |
Hilum distinct annular, shape variable, rings faint. |
| St. Vincent arrowroot |
Oval-oblong | 0.00148 to 0.00129 |
Hilum semi-lunar, rings faint, shape not very variable. |
| Natal arrowroot |
Broadly ovate | 0.00148 to 0.00129 |
Hilum annular, in center and well marked complete rings. |
| Galangal | Skittle-shaped | About 0.00135 | Hilum elongated, very faint incomplete rings. |
| Calumba | Broadly pear-shaped | ” 0.00185 | Hilum semi-lunar, faint but complete rings, shape variable. |
| Orris root | Elongated-oblong | ” 0.00092 | Hilum faint, shape characteristic. |
| Turmeric | Oval-oblong, conical | ” 0.00148 | Very strongly marked incomplete rings. |
| Ginger | Shortly conical, with rounded angles. |
” 0.00148 | Hilum and rings scarcely visible, shape variable but characteristic. |
Group II: With strongly developed hilum more or less stellate.
| Name. | Shape. | Normal measurements. |
Remarks. |
|---|---|---|---|
| Bean | Oval-oblong | About 0.00135 | Fairly uniform. |
| Pea | Like bean | 0.00111 to 0.00074 |
Very variable in size,with granules under preponderating. |
| Lentil | Like bean | About 0.00111 | Hilum, a long depression seldom radiate. |
| Nutmeg | Rounded | ” 0.00055 | The small size and rounded form distinctive. |
| Dari | Elongated hexagon | ” 0.00074 | Irregular appearance and great convexity distinctive. |
| Maize | Round and polygonal | ” 0.00074 | The rounded angles of the polygonalgranules distinctive. |
Group III: Hilum and rings practically invisible.
| Name. | Shape. | Normal measurements. |
Remarks. |
|---|---|---|---|
| Wheat | Circular and flat | 0.00185 to 0.00009 |
Very variable in size and very dull polarization in water. |
| Barley | Slightly angular circles | About 0.00073 | The majority measuring about 0.00373 distinctive, and a few four times this size. |
| Rye | Like barley | 0.00148 to 0.00009 |
Small granules, quite round, and here and there cracked. |
| Jalap | Like wheat | Polarizes brightly in water. | |
| Rhubarb | do. | 0.00055 to 0.00033 |
Polarizes between jalap and wheat, and runs smaller and more convex. |
| Senega | Like wheat | 0.00148-0.00009 | Measurements the only guide. |
| Bayberry | do. | 0.00074-0.00011 | |
| Sumbul | do. | 0.00074-0.00009 | |
| Chestnut | Very variable | 0.00090-0.00009 | Variable form, and small but regular size, distinctive. |
| Acorn | Round-oval | About 0.00074 | Small and uniform size, distinctive. |
| Calabar bean | Oval-oblong | 0.00296 to 0.00180 |
Large size and shape characteristic. |
| Licorice | Elongated-oval | About 0.00018 | Small size and shape distinctive. |
| Hellebore (green or black) |
Perfectly rotund | 0.00037 to 0.00009 |
Small, regular size and rotundity, distinctive. |
| Hellebore (white) |
Irregular | 0.00055 to 0.00009 |
Irregular shape and faint central depression, distinctive. |
Group IV: More or less truncated at one end.
| Name. | Shape. | Normal measurements. |
Remarks. |
|---|---|---|---|
| Cassia | Round | 0.00111 to 0.00018 |
Round or muller shaped granules and faint circular hilum. |
| Cinnamon | Like cassia | 0.00074 to 0.00009 |
More frequently truncated than cassia, and smaller. |
| Sago (raw) | Oval-ovate | 0.00260 to 0.00111 |
Has circular hilum at convex end and rings faintly visible. |
| Sago (prepared) | ” | 0.00260 to 0.00111 |
Has a large oval or circular depression, covering one-third nearly of each granule. |
| Tapioca | Roundish | 0.00074 to 0.00055 |
A little over fifty per cent truncated by one facet, and a pearly hilum. |
| Arum | Like tapioca | About 0.00056 | Smaller than tapioca and truncated by two facets. |
| Belladonna | do. | Not distinguishable from tapioca. | |
| Colchicum | do. | About 0.00074 | Larger than tapioca, and contains many more truncated granules. |
| Scammony | do. | ” 0.00045 | Smaller than tapioca, more irregular, and hilum not visible. |
| Cancella | Very variable | 0.00033-0.00022 | Very variable, form and small size the only points. |
| Podophyllum | Like tapioca | About 0.00040 | Like scammony, but has visible hilum in most of the granules. |
| Aconite | do. | ” 0.00037 | Like tapioca, but half the size. |
Group V: All granules more or less polygonal.
| Name. | Shape. | Normal measurements. |
Remarks. |
|---|---|---|---|
| Tacca | Poly- or hexagonal | 0.00075 to 0.00037 |
Distinguished from maize by its sharp angles. |
| Oat | Polygonal | About 0.00037 | Larger than rice and hilum visible in some granules. |
| Rice> | do. | 0.00030-0.00020 | Measurement using one-eighth or one-twelfth inch power, and then hilum visible. |
| Pepper | do. | 0.00020-0.00002 | Do. |
| Ipecacuanha | do. | About 0.00018 | Some round and truncated granules, adhering in groups of three. |
[Pg 218] 199. Blyth’s Classification.—Blyth gives the following scheme for the identification of starch granules by their microscopic appearance.[165]
Division I.—Starches showing a play of colors with polarized light and selenite plate:
The hilum and concentric rings are clearly visible, and all the starch granules, oval or ovate. Canna arrowroot, potato, arrowroot, calumba, orris root, ginger, galangal and turmeric belong to this division.
Division II.—Starches showing no iridescence, or scarcely any, when examined by polarized light and selenite:
Class I.—The concentric rings are all but invisible, and the hilum stellate. The bean, pea, maize, lentil, dari and nutmeg starches are in this class.
Class II.—Starches which have both the concentric rings and hilum invisible in the majority of granules: this important class includes wheat, barley, rye, chestnut, acorn, and many starches in medicinal plants.
Class III.—All the granules are truncated at one end. This class includes sago, tapioca and arum, several drugs and cinnamon and cassia.
Class IV.—In this class all the granules are angular in form and it includes oats, tacca, rice, pepper and ipecacuanha.
200. Preparation of Starches for Microscopical Examination.—The approximately pure starches of commerce may be prepared for microscopic examination by rubbing them up with water and mounting some of the suspended particles by one of the methods to be described below.
In grains, seeds and nuts the starch is separated by grinding with water and working through fine linen. The starch which is worked through is allowed to subside, again beaten up with water if necessary and the process continued until the grains are separated sufficiently for microscopic examination. A little potash or soda lye may be used, if necessary, to separate the granules from albuminous and other adhering matter. The analyst should have a collection of samples of all common starches of known origin for purposes of comparison. [Pg 219]
The granules are mounted for examination by plain light in a medium of glycerol and camphor water. When polarized light is used the mounting should be in Canada balsam.[166] The reader can find excellent photomicrographs of the more common starches in Griffith’s book.[167]
201. Appearance in Balsam with Polarized Light.—Mounted in balsam the starches are scarcely visible under any form of illumination with ordinary light, the index of refraction of the granules and the balsam being so nearly alike. When, however, polarized light is used the effect is a striking one. It is very easy to distinguish all the characteristics, except the rings, the center of the cross being at the nucleus of the granule.
With the selenite plate a play of colors is produced, which is peculiar to some of the starches and forms the basis of Blyth’s classification.
202. Description Of Typical Starches.—The more commonly occurring starches are described by Richardson as they appear under the microscope magnified about 350 diameters.[168]
The illustrations, with the exception of the cassava starch, and the maize starch accompanying it were drawn by the late Dr. Geo. Marx from photographs made by Richardson in this laboratory. The two samples excepted were photographed for the author by Dr. G. L. Spencer.
Maranta Starch.—Of the same type as the potato starch are the various arrowroots, the only one of which commonly met with in this country being the Bermuda, the starch of the rhizome of Maranta arundinacea, and the starch of turmeric.
The granules are usually not so varied in size or shape as those of the potato, averaging about 0.07 millimeter in length as may be seen in Fig. 48. They are about the same size as the average of the potato, but are not often found with the same maximum or minimum magnitude, which circumstance, together with the fact that the end at which the nucleus appears is broader in the maranta and more pointed in the potato, enables one to distinguish the two starches without difficulty. With polarized light the results are similar to those seen with potato starch, and this is a ready means of distinguishing the two varieties, [Pg 220] by displaying in a striking way the form of the granule and position of the hilum.
Potato Starch.—The starch grains of the potato are very variable in size, being found from 0.05 to 0.10 millimeter in length, and in shape from oval and allied forms to irregular and even round in the smallest. These variations are illustrated in Fig. 49, but the frequency of the smaller granules is not as evident as in some other cases. The layers are visible in some granules with great distinctness and in others hardly at all, being rather more prominent in the starch as obtained from a freshly cut surface. The rings are more distinct, too, near the hilum or nucleus, which in this, as in all tuberous starches, is eccentric, shading off toward the broader or more expanded portion of the granule. The hilum appears as a shadowy depression, and with polarized light its position is well marked by the junction of the arms of the cross. With polarized light and a selenite plate a beautiful play of colors is obtained. The smaller granules, which are nearly round, may readily be confused with other starches, but their presence serves at once to distinguish this from maranta or Bermuda arrowroot starch. Rarely compound granules are found composed of two or three single ones each with its own nucleus.
Ginger Starch.—This starch is of the same class as those from the potato and maranta and several others which are of underground origin. In outline the granules are not oval like those named, but more rectangular, having more obtuse angles in the larger ones and being cylindrical or circular in outline in the smaller, as indicated in Fig. 50. They average nearly the same size as maranta starch, but are much more variable, both in size and form. The rings are scarcely visible even with the most favorable illuminations.
Sago Starch.—This exists in two modifications in the market; as raw and as prepared sago. In the prepared condition it is characterized by a larger circular depression in the center of most of the granules. The rings are not visible. They are mostly circular in form or approaching it, and vary from 0.025 to 0.065 millimeter in diameter, as indicated in Fig. 51.
Fig. 48.

Maranta Starch × 350.
Fig. 49.

Potato Starch × 350.
Fig. 50.

Ginger Starch × 350.
Fig. 51.

Sago Starch × 350.
Fig. 52.

Pea Starch × 350.
Fig. 53.

Bean Starch × 350.
DRAWN BY GEO. MARX.A. Hoen & Co., Lithocaustic
Fig. 54.

Wheat Starch × 350.
Fig. 55.

Barley Starch × 350.
Fig. 56.

Rye Starch × 350.
Fig. 57.

Oat Starch × 350.
Fig. 58.

Indian Corn Starch × 350.
Fig. 59.

Rice Starch × 350.
DRAWN BY GEO. MARX.A. Hoen & Co., Lithocaustic
FIG. 60.
Cassava Starch × 150.
PLAIN ILLUMINATION.
FIG. 61.

Indian Corn Starch × 150.
PLAIN ILLUMINATION.
A. Hoen & Co., Lithocaustic
[Pg 221] Pea and Bean Starches.—These starches produce but a slight effect with polarized light. The rings are scarcely visible, and the hilum is stellate or much cracked along a median line, the bean more so than the pea, the latter resembling fresh dough kneaded again into the center as in making rolls, and the former the shape assumed by the same after baking. The grains of both are somewhat variable in size, ranging from 0.025 to 0.10 millimeter in length, as shown in Figs. 52 and 53.
Wheat Starch grains are quite variable in size, varying from 0.05 to 0.010 millimeter in diameter. They belong to the same class as barley and rye, the hilum being invisible and the rings not prominent. The granules are circular disks in form, and there are now and then contorted depressions resembling those in pea starch. They are the least regular of the three starches named and do not polarize actively. The typical forms of these granules are shown in Fig. 54.
Barley Starch is quite similar to that of wheat, but the grains do not vary so much in size, averaging 0.05 millimeter. They have rings which are much more distinct, and very small granules adhering to the largest in bud-like forms, as seen in Fig. 55.
Rye Starch is more variable in size, many of the granules not exceeding 0.02 millimeter, while the largest reach 0.06 to 0.07 millimeter. It lacks distinctive characteristics entirely, and is the most simple in form of all the starches. Fig. 56 shows the appearance of the granules under the microscope.
Oat Starch is unique, being composed of large compound masses of polyhedral granules from 0.12 to 0.02 millimeter in length, the single granules averaging 0.02 to 0.015 millimeter. It does not polarize actively, and displays neither rings nor hilum. The illustration, Fig. 57, shows its nature with accuracy.
Indian Corn Starch.—The granules of maize starch are largely of the same size, from 0.02 to 0.03 millimeter in diameter, with now and then a few which are much smaller. They are mostly circular in shape or rather polyhedral, with rounded angles, as shown in Figs. 58 and 61. They form very brilliant objects with polarized light, but with ordinary illumination show but the faintest sign of rings and a well-developed hilum, at times star-shaped, and at others more like a circular depression.
Rice Starch is very similar to that of maize, and is easily [Pg 222] confused with it, the grains being about the same size. The grain, however, is distinguished from it by its polygonal form, and its well defined angles, as indicated in Fig. 59. The hilum is more prominent and more often stellate or linear. Several granules are at times united.
Cassava Starch.—This variety of starch is obtained from the root of the sweet cassava, which grows in great profusion in Florida. It is compared with maize starch in Figs. 60 and 61. In the illustration the granules are represented as magnified 150 diameters. The grains of the cassava starch measure about 0.012 millimeter in diameter and resemble very nearly maize starch, except that they have greater evenness of outline.[169]
For further descriptions of starch grains the reader is referred to the work of Griffith, already cited.
These descriptions, it will be seen, do not agree entirely with those of some other authors, but they are based on a somewhat extensive experience.
There are peculiarities of size, shape and appearance of starch granules, which must be allowed for, and the necessity for every investigator to compare a starch which he is desirous of identifying with authentic specimens, must always be recognized.
[23] Vines, Vegetable Physiology.
[24] Berichte der deutschen chemischen Gesellschaft, Band 23, S. 2136; Stone, Agricultural Science Vol. 6, p. 180. Page 59, eighth line from bottom insert “original” before “optical.” Page 60, second line from top, read d instead of l fructose.
[25] Herles, Zeitschrift des Vereins für die Rübenzucker-Industrie, 1890. S. 217.
[26] Tucker; Wiechmann; Sidersky; von Lippman; Tollens and Spencer.
[27] Bulletin No. 28, Department of Agriculture, Division of Chemistry, p. 197.
[28] Physikalisch-Chemische Tabellen, S. 42.
[29] Tucker’s Manual of Sugar Analysis, pp. 100 et seq.
[30] Vid. op. cit. supra, p. 108.
[31] Op. cit. supra, p. 109.
[32] Op. cit. supra, p. 110.
[33] Op. cit. supra, p. 114.
[34] Spencer’s Handbook for Sugar Manufacturers, p. 92.
[35] Landolt’s Handbook of the Polariscope, pp. 95 et seq.
[36] Robb, vid. op. cit. supra, p. 8.
[37] Spencer’s Handbook for Sugar Manufacturers, pp. 22 et seq. Tucker’s Manual of Sugar Analysis, pp. 120 et seq.
[38] Sidersky; Traité d’Analyse des Matières Sucrées, p. 104.
[39] Journal of the American Chemical Society, 1893. Vol. 15, p. 121.
[40] Comptes rendus, 1879. Seance du 20th Octobre 1879; Dingler’s polytechniches Journal, Band 223, S. 608.
[41] Landolt’s Handbook of the Polariscope. p. 120.
[42] Sidersky; Traité d’Analyse des Matières Sucrées, p. 97.
[43] Manual of Sugar Analysis, pp. 143 et seq.
[44] Landolt und Börnstein, Physikalisch-Chemische Tabellen. S. 460.
[45] Bulletin No. 31. Department of Agriculture, Division of Chemistry, p. 232.
[46] Zeitschrift des Vereins für die Rübenzucker-Industrie. 1870, S. 223.
[47] Tucker’s Manual of Sugar Analysis, p. 164.
[48] (bis). Gerlach, Spencer’s Handbook for Sugar Manufacturers, p. 91.
[49] Vid. op. cit. supra, p. 45.
[50] Vid. loc. et op. cit. supra.
[51] Gill; Journal of the Chemical Society, Vol. 24, 1871, p. 91.
[52] Wiley; American Chemical Journal, Vol. 6, p. 289.
[53] Vid. op. cit. supra, p. 301.
[54] Zeitschrift des Vereins für die Rübenzucker-Industrie, 1890. S. 876.
[55] Weber and McPherson; Journal of the American Chemical Society. Vol. 17, p. 320; Bulletin No. 43. Department of Agriculture, Division of Chemistry, p. 126.
[56] Zeitschrift des Vereins für die Rübenzucker-Industrie, 1888, S. 51.
[57] Vid. op. cit. supra, Ss, 699 und 763; 1890. S. 217.
[58] Bulletin de l’Association des Chimistes de Sucrerie et de Distillerie, May, 1890, p. 431.
[59] Neue Zeitschrift für Rübenzucker-Industrie, Band 19, S. 71.
[60] Journal of the Chemical Society, Transactions, Vol. 57, pp. 834, et seq.
[61] Op. cit. supra, p. 866.
[62] Op. cit. supra, 1891, p. 46.
[63] Neue Zeitschrift für Rübenzucker-Industrie, Band 19, S. 71.
[64] From γῦρος and δῦνᾶτός (δύνᾶμις).
[65] Landolt’s Handbook of the Polariscope, p. 125.
[66] Vid. op. cit. supra, pp. 48 et seq.
[67] Berichte der deutschen chemischen Gesellschaft, 1877, S. 1403.
[68] Die landwirtschaftlichen Versuchs-Stationen, Band 40, S. 307.
[69] Spencer’s Handbook for Sugar Manufacturers, p. 80; Landolt’s Handbook of the Polariscope, p. 216; Tollens’ Handbuch der Kohlenhydrate.
[70] Annalen der Chemie and Pharmacie, May, 1870.
[71] Tucker’s Manual of Sugar Analysis, p. 208.
[72] Rapport fait a la Société d’Encouragement d’Agriculture; Journal de Pharmacie et de Chimie, 1844. 3d serie, Tome 6, p. 301.
[73] Annalen der Chemie und Pharmacie, Band 39, S. 361.
[74] Jahrbücher für praktische Heilkunde, 1845, S. 509.
[75] Archives für Physiologische Heilkunde, 1848, Band 7, S 64.
[76] Rodewald and Tollens; Berichte der deutschen chemischen Gesellschaft, Band 11, S. 2076.
[77] Chemical News, Vol. 39, p. 77.
[78] The Analyst, Vol. 19, p. 181.
[79] Gaud; Bulletin de l’Association des Chimistes de Sucrerie et de Distillerie, Apr. 1895, p. 629; Comptes rendus, 1894, Tome 119, p. 604.
[80] Annalen der Chemie und Pharmacie, B. 72, S. 106.
[81] Journal of Analytical and Applied Chemistry, Vol. 4, p. 370.
[82] Wiley; Bulletin de l’Association des Chimistes de Sucrerie et de Distillerie, April, 1884.
[83] Vid. op. cit. supra, 1895, p. 642; Comptes rendus, Tome 119, 1894, p. 650.
[84] Annual Report, United States Department of Agriculture, 1879, p. 65; Zeitschrift für Analytische Chemie, Band 12, S. 296; Mohr Titrirmethode, sechste auflage, S. 508.
[85] Comptes rendus, 1894, Tome 119, p. 478.
[86] Gazetta Chimica Italiana, Tome 6, p. 322.
[87] Sidersky; Traité d’Analyse des Matières Sucrées, p. 148.
[88] Vid. op. cit. supra, p. 149.
[89] Neue Zeitschrift für die Rübenzucker-Industrie, Band 22, S. 220.
[90] Zeitschrift des Vereins für Rübenzucker-Industrie, 1889, S. 933.
[91] Vid. op. cit. supra, 1887, S. 147.
[92] Berichte der deutschen chemischen Gesellschaft, Band 23, No. 14, S. 3003; Zeitschrift des Vereins für die Rübenzucker-Industrie, 1891, S. 97.
[93] Ost; vid. op. et loc. cit. supra.
[94] Zeitschrift des Vereins für die Rübenzucker-Industrie, 1890, S. 187.
[95] Chemical News, Vol. 39, p. 77.
[96] The Analyst, 1894, p. 181.
[97] Chemical News, Vol. 71, p. 235.
[98] Journal de Pharmacie et de Chimie, 1894, Tome 30, p. 305.
[99] Pharmaceutical Journal, (3), 23, p. 208.
[100] Vid. op. cit. supra, (3), 25, p. 913.
[101] Sidersky; Bulletin de l’Association des Chimistes, Juillet, 1886 et Sept. 1888.
[102] Bodenbender and Scheller; Zeitschrift des Vereins für die Rübenzucker-Industrie, 1887, S. 138.
[103] Vid. op. cit. supra, 1889, S. 935.
[104] Ewell; Manuscript communication to author.
[105] Journal für praktische Chemie, 1880, Band 22, 46; Handbuch der Spiritusfabrication, 1890, S. 79; Zeitschrift des Vereins für die Rübenzucker-Industrie, 1879, S. 1050; Ibid, 1883, S. 769; Ibid, 1889, S. 734.
[106] Handbuch der Spiritusfabrication, 1890, 79.
[107] Wein; Tabellen zur quantitativen Bestimmung der Zuckerarten, S. 13. (The caption for the table on page 159 should read as on page 160.)
[108] Zeitschrift des Vereins für die Rübenzucker-Industrie, 1889, S. 735.
[109] Bulletin No. 43, Department of Agriculture, Division of Chemistry, p. 209.
[110] Chemiker-Zeitung, 1893, S. 548.
[111] Wein; Tabellen zur quantitativen Bestimmung der Zuckerarten, S. 35.
[112] Berichte der deutschen chemischen Gesellschaft, Band 16, S. 661.
[113] Vid. op. cit. supra, Band 22, S. 87.
[114] Chemisches Centralblatt, 1895, Band 2, S. 66.
[115] Comptes rendus; Tome 112, No. 15, p. 799.
[116] Vid. op. cit. supra, Tome 94, p. 1517.
[117] Journal of the Chemical Society, June, 1888, p. 610. (In the formulas for lactose and arabinose read H₂₂ and H₁₀ respectively.)
[118] American Chemical Journal, Vol. 11, No. 7, p. 469.
[119] Chemisches Centralblatt, 1889, No. 7.
[120] American Chemical Journal, Vol. 17, No. 7, pp. 507, 517.
[121] Comptes rendus, Tome 118, p. 426.
[122] Justus Liebig’s Annalen der Chemie, 1890. Band 257, S. 160.
[123] Journal of Analytical and Applied Chemistry, Vol. 7, pp. 68 et seq.
[124] Flint and Tollens; Berichte der deutschen chemischen Gesellschaft, Band 25, S. 2912.
[125] Vid. op. cit. supra, Band 23, S. 1751. (Read Günther.)
[126] Journal of Analytical and Applied Chemistry, Vol. 5, p. 421.
[127] Vid. op. cit. supra, p. 426.
[128] Berichte der deutschen chemischen Gesellschaft, Band 24, S. 3575.
[129] Journal of Analytical and Applied Chemistry, Vol. 7, p. 74.
[130] Chemiker-Zeitung, Band 17, 1743.
[131] Vid. op. cit. supra, Band 18, N. 51, S. 966.
[132] Monatshefte für Chemie, Band 16, S. 283; Berichte der deutschen chemischen Gesellschaft, Referate Band 28, S. 629.
[133] Papasogli; Bulletin de l’Association des Chimistes de Sucrerie et de Distillerie, Juillet 1895, p. 68.
[134] Gans und Tollens; Zeitschrift des Vereins für die Rübenzucker-Industrie, Band 38, S. 1126.
[135] Berichte der deutschen chemischen Gesellschaft, 20, S. 181; Zeitschrift des Vereins für die Rübenzucker-Industrie, 1891, S. 895.
[136] Zeitschrift des Vereins für die Rübenzucker-Industrie, 1891, S. 891.
[137] Chemiker-Zeitung, 1888, No. 2; Zeitschrift des Vereins für die Rübenzucker-Industrie, 1888, S. 347.
[138] Fischer; Berichte der deutschen chemischen Gesellschaft, Band 20, S. 821; Band 21, Ss. 988; 2631.
[139] Zeitschrift für physiologische Chemie, Band 11, S. 492.
[140] Vid. op. cit. supra, Band 12, No. 4, Ss. 355 et seq; No. 5, Ss. 377 et seq.
[141] Berichte der deutschen chemischen Gesellschaft, Band 20, S. 540.
[142] Sitzungsberichte der Mathematisch-Naturwissenschaften in Wien, Band 93, Heft 2, S. 912.
[143] Tollens; Handbuch der Kohlenhydrate; von Lippmann, Chemie der Zuckerarten.
[144] Wilder Quarter-Century Book, 1893; Abdruck aus dem Centralblatt für Bakteriologie und Parasitenkunde, Band 18, 1895, No. 1; American Journal of Medical Sciences, Sept., 1895.
[145] Griffiths, Principal Starches used as Food; Nägeli’s Beiträge zur näheren Kenntniss der Stärkegruppe.
[146] Zeitschrift für Physiologische Chemie, Band 12, Ss. 75-78.
[147] Maercker; Handbuch der Spiritusfabrikation, 1890, S. 90.
[148] Chemiker-Zeitung, Band 19, S. 1501.
[150] Vol. 2, p. 204.
[151] Chemisches Centralblatt, 1877, Band 8, S. 732.
[152] Chemiker-Zeitung, Band 19, S. 1501.
[153] Vid. op. cit. supra, S. 1502; Moniteur Scientifique, 1887, p. 538.
[154] Chemiker-Zeitung, Band 19, S. 1502.
[155] Vid. op. cit. supra, 1895, S. 1727.
[156] Chemiker-Zeitung, Band 19, S. 1502.
[157] Jahresberichte der Agrikulturchemie, 1892, S. 664.
[158] Journal de Pharmacie et de Chimie, 5ᵉ, Série, Tome 25, p. 394.
[159] Journal of the American Chemical Society, Vol. 17, p. 64.
[160] Repertorium der Analytischen Chemie, 1887, S. 299.
[161] Journal of the American Chemical Society, Vol. 16, p. 726.
[162] Förschungs Berichte über Lebensmittel, Hamburg; Abs., The Analyst, Vol. 20, p. 210.
[163] Rouvier; Comptes rendus, Tome 107, pp. 272, 278; Tome 111, pp. 64, 186; Tome 120, p. 1179.
[164] Bulletin 13, Department of Agriculture, Division of Chemistry, pp. 154 et. seq.
[165] Foods, Their Composition and Analysis, p. 139.
[166] Richardson, Vid. op. cit. 142, p. 158.
[167] Principal Starches used as Food, Cirencester, Baily & Son, Market Place.
[168] Vid. op. cit. 142, pp. 158 et seq.
[169] Bulletin 44, Department of Agriculture, Division of Chemistry, p. 14.
203. Introduction.—In the preceding part directions have been given for the estimation of sugars and starches in approximately pure forms. In the present part will be described the most approved methods of separating these bodies and other carbohydrates from crude agricultural products and for their chemical examination. In many respects the processes which in a small way are used for preparing samples for analysis are employed on a large scale for technical and manufacturing purposes. It is evident, however, that the following paragraphs must be confined strictly to the analytical side of the question inasmuch as anything more than mere references to technical processes would lead into wide digressions.
In the case of sugars the analyst is for the most part quite as much in need of reliable methods of extraction and preparation as of processes for analysis. With starches the matter is more simple and the chief methods of separating them for examination were necessarily described in the previous part.
Sugars in fresh plants exist almost entirely in solution. This is true of all the great sources of the sugar of commerce, viz., the palm, the maple, the sugar beet and sugar cane. This statement is also true of fruits and the natural nectar of flowers. By natural or artificial drying the sugar may be reduced to the solid or semisolid state as in the cases of raisins and honey. In certain seeds, deficient in water, sugars may possibly exist in a solid state naturally, as may be the case with sucrose in the peanut and raffinose in cotton seed. [Pg 228]
Starches on the other hand when soluble, are probably not true starches, but they partake more or less of a dextrinoid nature. Fine starch particles occur abundantly in the juices of some plants, as for instance sorghum, where they are associated with sugar and can be obtained from the expressed juice by subsidence. But even in such a case it is not certain that the starch enters into the general circulation. It is more likely formed locally by biochemical condensation of its constituents. Starches in a soluble or semisoluble state are transported, as a rule, to the tubers or seeds of plants where they are accumulated in large quantities as a reserve food for future growth. For a study of the plant metabolism whereby starch is produced and for its histological and physiological properties the reader may consult the standard authorities on vegetable physiology.[170]
204. Sugar in the Sap of Trees.—Many trees at certain seasons of the year, carry large quantities of sugar in their sap. Among these the maple and sugar palm are preeminent. The sap is secured by cutting a pocket into the side of the tree or by boring into it and allowing the sap to run into an appropriate receptacle through a spile. The content of sugar in the sap of the maple and palm varies greatly. In some cases it falls as low as one and a half and in others rises to as much as six or seven per cent.[171] In most cases the sugar in the maple sap is pure sucrose, but towards the end of the flowing season it may undergo changes of a viscous nature due to fermentation, or inversion, forming traces of invert sugar. In this country the sap of the maple may flow freely on any warm day in winter, but the sugar season proper begins about February 15th in Southern Ohio and Indiana, and about March 25th in Vermont. It lasts from six weeks to two months. The sap flows best during moderately warm, still days, after a light freeze.
In addition to sugar the maple sap contains a trace of albuminoid matters and some malic acid combined with lime. As a rule it can be subjected to polarization without preliminary clarification.
205. Determination of Sugar in Saps.—In most cases the sap may be directly polarized in a 200 millimeter tube. Its specific gravity is [Pg 229] obtained by a spindle or pyknometer, and the percentage of sugars taken directly from the table on page 73, the degree brix corresponding to the sugar percentage.
On polarizing, the sugar percentage is calculated as follows:
Multiply the specific gravity of the sap by 100 and divide the product by 26.048. Divide the direct reading of the sap on the sugar scale by the quotient obtained above, and the quotient thus obtained will be the correct percentage of sugar in the original solution.
The formula is applicable for those instruments in which 26.048 grams represent the normal quantity of sugar which in 100 cubic centimeters reads 100 divisions on the scale. When other factors are used they should be substituted for 26.048 in the above formula.
The principle of the calculation is based on the weight of the sap which is contained in 100 cubic centimeters, and this is evidently obtained by multiplying 100 by the specific gravity of the sap. Since 26.048 is the normal quantity of sugar in that volume of the solution the quotient of the actual weight divided by that factor shows how many times too great the observed polarization is. The simple division of the polariscope reading by this factor gives the correct reading.
Example: Let the specific gravity of the sap be 1.015 and the observed polarization be 15.0. Then the true percentage of sugar in the sap is found by the equation:
101.5 : 26.048 = 15.0 : x.
Whence x = 3.85 = percentage of sugar in the sap.
The process outlined above is not applicable when a clarifying reagent such as lead subacetate or alumina cream must be used. But even in these cases it will not be found necessary to weigh the sap. A sugar flask graduated at 100 and 110 cubic centimeters is used and filled to the first mark with the sap, the specific gravity of which is known. The clarifying reagent is added, the volume completed to the second mark with water, and the contents of the flask well shaken and thrown on a dry filter. The observation tube, which should be 220 millimeters in length, is then filled with the clear filtrate and the rest of the process is as described above. A 200 millimeter tube may also be used in [Pg 230] this case and the observed reading increased by one-tenth.

Fig. 62.
Laboratory Cane Mill.

Fig. 63.
Weighing
Pipette.
206. Estimation of Sugar in the Sap of Sugar Cane and Sorghum.—In bodies like sugar cane and sorghum the sap containing the sugar will not flow as in the cases of the maple and sugar palm. The simplest way of securing the sap of the bodies named is to subject them to pressure between rolls. A convenient method of obtaining the sap or juice is by passing the cane through a small three-roll mill indicated in the figure. Small mills of this kind have been used in this division for many years and with entire satisfaction. Small canes, such as sorghum, may be milled one at a time, or even two or three when they are very small. In the case of large canes, it is necessary that they be split and only half of them used at once. The mill should not be crowded by the feed in such a way as to endanger it or make it too difficult for the laborer to turn. From fifty to sixty per cent of the weight of a cane in juice may be obtained by passing it through one of these small mills. Experience has shown that there is a little difference between the juice as first expressed and the residual sap remaining in the bagasse, but the juice first expressed may be used for analysis for control purposes as a fair representative of all that the cane contains.
To determine the percentage of juice expressed, the canes may be weighed before passing through the mill and the juice collected. Its weight divided by the weight of the original cane will give the per cent of the juice expressed, calculated on the whole cane. Instead of weighing the juice the bagasse may also be collected and weighed; but on account of the rapidity with which it dries the operation should be [Pg 231] accomplished without delay. The expressed juice is clarified with lead subacetate, filtered and polarized in the manner described in former paragraphs. Instead of weighing the juice, its specific gravity may be taken by an accurate spindle and the volume of it, equivalent to a given weight, measured from a sucrose pipette.[172]
A sucrose pipette for cane juice has a graduation on the upper part of the stem which enables the operator to deliver double the normal weight for the polariscope used, after having determined the density of the juice by means of a spindle. A graduation of from 5° to 25° of the brix spindle will be sufficient for all variations in the density of the juice, or one covering a range of from 10° to 20° will suffice for most instances. The greater the density of the juice the less volume of it will be required for the weight mentioned. For general use, the sucrose pipette is graduated on the stem to deliver from forty-eight to 50.5 cubic centimeters, the graduations being in terms of the brix spindle. The graduation of the stem of this instrument is shown in the accompanying figure. In the use of the pipette it is only necessary to fill it to the degree on the stem corresponding to the degree brix found in the preliminary trial.
The quantities of juice corresponding to each degree and fractional degree of the brix spindle are given in the following table; calculated for the normal weight 26.048 grams for the ventzke and for 16.19 grams for the laurent scale. The measured quantities of juice are placed in a 100 cubic centimeter sugar flask, treated with the proper quantity of lead subacetate, the volume completed to the mark, and the juice filtered and polarized in a 200 millimeter tube. The reading of the polariscope is divided by two for the factor 26.048 and by three for the factor 16.19. [Pg 232]
Table for Use of Sucrose Pipettes.
| Degrees brix. |
Cubic centimeters of juice for 26.048 factor. Divide reading by two. |
Degrees brix. |
Cubic centimeters of juice for 16.19 factor. Divide reading by three. |
|---|---|---|---|
| 5.0 | 51.1 | 5.0 | 47.6 |
| 5.4 | 51.0 | 5.7 | 47.5 |
| 5.7 | 50.9 | 6.3 | 47.4 |
| 6.4 | 50.8 | 6.8 | 47.3 |
| 6.9 | 50.7 | 7.3 | 47.2 |
| 7.4 | 50.6 | 7.8 | 47.1 |
| 7.9 | 50.5 | 8.3 | 47.0 |
| 8.4 | 50.4 | 8.9 | 46.9 |
| 8.9 | 50.3 | 9.5 | 46.8 |
| 9.4 | 50.2 | 10.0 | 46.7 |
| 9.9 | 50.1 | 10.5 | 46.6 |
| 10.4 | 50.0 | 11.0 | 46.5 |
| 10.9 | 49.9 | 11.6 | 46.4 |
| 11.4 | 49.8 | 12.1 | 46.3 |
| 11.9 | 49.7 | 12.7 | 46.2 |
| 12.4 | 49.6 | 13.3 | 46.1 |
| 12.9 | 49.5 | 13.8 | 46.0 |
| 13.4 | 49.4 | 14.3 | 45.9 |
| 13.9 | 49.3 | 14.8 | 45.8 |
| 14.4 | 49.2 | 15.3 | 45.7 |
| 14.9 | 49.1 | 15.9 | 45.6 |
| 15.4 | 49.0 | 16.4 | 45.5 |
| 15.9 | 48.9 | 17.0 | 45.4 |
| 16.4 | 48.8 | 17.5 | 45.3 |
| 16.9 | 48.7 | 18.0 | 45.2 |
| 17.4 | 48.6 | 18.6 | 45.1 |
| 17.9 | 48.5 | 19.1 | 45.0 |
| 18.4 | 48.4 | 19.7 | 44.9 |
| 18.9 | 48.3 | 20.2 | 44.8 |
| 19.4 | 48.2 | ||
| 19.9 | 48.1 |
In ordering sucrose pipettes the factor for which they are to be graduated should be stated.
It is evident also that with the help of the foregoing table the measurements may be made by means of a burette. For instance, if the degree brix is found to be 19.9, 48.1 cubic centimeters are to be used. This quantity can be easily run from a burette. In order to make the pipette more convenient it has been customary in this laboratory, as practiced by Carr, to attach a glass tube with a stopcock by means of [Pg 233] a rubber tube to the upper part of the pipette, whereby the exact level of the juice in the stem of the pipette can be easily set at any required mark.
In the polarization of dilute solutions, such as are found in the saps and juices referred to above, it must not be forgotten that the gyrodynat of the sucrose is increased as the density of the solution is diminished. This change introduces a slight error into the work which is of no consequence from a technical point of view, but becomes a matter which must be considered in exact determinations. To avoid the annoyance of calculating the gyrodynat for every degree of concentration, tables have been constructed by Schmitz and Crampton by means of which the actual percentage of sugar, corresponding to any degree of polarization, is determined by inspection. These tables may be used when extremely accurate work is required.[173]

Figure 64. Gird’s
Gravimeter.
207. Measuring Sugar Juices with a Gravimeter.—A convenient method of weighing sugar juices is the gravimetric process designed by Gird.[174] The apparatus is fully illustrated by Fig. 64. The hydrometer F has a weight of 26.048 grams and its stem is also graduated in degrees brix. The juice is poured into the cylinder A and allowed to stand until air bubbles have escaped. In filling A the finger is held over the orifice G so that the siphon tube B is completely filled, the air escaping at the vent C. After the tube is filled the finger is withdrawn from G and all the liquid which will run out at G allowed to [Pg 234] escape. The sugar flask D is now brought under G and the hydrometer F allowed to descend into A. The hydrometer will displace exactly its own weight of liquid. For convenience of reading, the index E may be used which is set five degrees above the surface of the liquid in A. The number of degrees brix read by E is then diminished by five. The hydrometer has been improved since the description given by the addition of a thermometer which, in addition to carrying a graduation in degrees, also shows the correction to be made upon the degree brix for each degree read. It is evident that the hydrometer may be made of any weight, and thus the delivery of any desired amount of juice be secured.
208. Determination of Reducing Bodies in Cane Juices.—Sucrose in cane juices is constantly accompanied with reducing sugars, or other bodies which have a similar action on fehling liquor, which interfere to a considerable degree with the practical manufacture of sugar. It is important to determine with a moderate degree of accuracy the quantity of these bodies. These sugars or reducing bodies are of a peculiar nature. The author pointed out many years ago that these reducing bodies were without action on polarized light, and for this reason proposed the name anoptose as one characteristic of their nature.[175] It is also found that these bodies do not yield theoretically the quantity of alcohol which a true sugar of the hexose type would give.[176] It is entirely probable, therefore, that they are quite different in their nature from many of the commonly known sugars. On account of the difficulty of separating these bodies in a pure state their actual copper reducing power is not known. For practical purposes, however, it is assumed to be the same as that of dextrose or invert sugar and the percentage of these bodies present is calculated on that assumption. In the determination of these sugars or reducing bodies, the quantity weighed may be determined by an apparatus entirely similar to the sucrose pipette just described above. The quantity of juice used should be diluted as a rule to such a degree as not to contain more than one per cent of the reducing bodies. For the best work, the juices should be clarified with lead subacetate and the excess of lead removed with sodium carbonate. For technical control work in sugar factories, this [Pg 235] process may be omitted as in such cases rapidity of work is a matter of considerable importance and the approximate estimation of the total quantity of reducing bodies is all that is desired.
For volumetric work, the solution of copper and the method of manipulation described in paragraph 117 are most conveniently used.
209. Preservation of Sugar Juices for Analysis.—Lead subacetate not only clarifies the juices of canes and thus permits of their more exact analytical examination, but also exercises preservative effects which enable it to be used as a preserving agent and thus greatly diminish the amount of work necessary in the technical control of a sugar factory. Instead, therefore, of the analyst being compelled to make an examination of every sample of the juice, aliquot portions representing the different quantities can be preserved and one analysis made for all. This method has been thoroughly investigated by Edson, who also finds that the errors, which may be introduced by the use of the lead subacetate in the analytical work, may be entirely avoided by using the normal lead acetate.[177]
In the use of the normal lead acetate, much less acetic acid is required in the polariscopic work than when the subacetate is used. The normal lead acetate is not so good a clarifying agent as the subacetate, but its efficiency in this respect is increased by the addition of a little acetic acid. In its use, it is not necessary to remove the lead, even for the determination of the reducing bodies.
For further details in regard to the technical determination of reducing bodies, special works may be consulted.[178]
210. Direct Determination of Sugars in Canes.—The methods, which have just been described, of securing the juices of cane by pressure and of determining the sugars therein, do not give the actual percentage of sugar in the cane. An approximate result may be secured by assuming that the cane is composed of ninety parts of juice and ten parts of cellular tissues and other insoluble matters. This assumption is approximately true in most cases, but there are often conditions arising which render the data calculated on the above assumption misleading. In any particular case in order to be certain that the [Pg 236] correct percentage of sugar is secured it will be necessary to determine the fiber in the cane. This is an analytical process of considerable labor and especially so on account of the difficulty of securing samples which represent the average composition of the cane. The fibrous structure of the canes, the hardness of their external covering and the toughness of their nodes or joints render the sampling extremely difficult. Moreover, the content of sugar varies in different parts of the cane. The parts nearest the ground are, as a rule, richer than the upper joints and this is especially true of sugar cane. In order, therefore, to get a fair sample, even of a single cane, all parts of it must be considered. Several methods of the direct determination of sugar in canes have been proposed and will be described below.

Figure 65. Machine for Cutting Canes.
211. Methods of Cutting or Shredding the Cane for Analytical Purposes.—A simple method of cutting canes into small pieces which will permit of an even sampling is very much to be desired. The cutting [Pg 237] apparatus shown in Fig. 65 has been long in use in this laboratory. The canes by it are cut into thin slices, but the cutting edge of the knife being perpendicular to the length of the cane renders the use of the instrument somewhat laborious and unsatisfactory. A considerable time is required to cut a single cane and the slices which are formed should be received in a vessel which will protect them as much as possible from evaporation during the process of the work. Instead of the apparatus above a small cane cutting machine arranged with four knives on a revolving disk maybe used. The apparatus is shown in Fig. 66. The cane is fed against the knives through the hole shown in the open front of the apparatus and the knives thus strike the cane obliquely.[179] The knives can be set in the revolving disk at any desired position so as to cut the canes into chips as fine as may be desired. The cossettes furnished by this method may be sampled directly for the extraction of the sugar. In the case of the cossettes from both instruments described above a finer subdivision may be secured by passing them through a sausage cutter.

Figure 66. Cane Cutting Mill.
The best method for shredding canes, however, is to pass them through the apparatus described on page 9. That machine gives an extremely fine, moist mass, which is of uniform nature and capable of being directly sampled.
[Pg 238] 212. Methods of Determination.—Even the finely divided material obtained by the machine just described is not suited to give an instantaneous diffusion for polarization as is done by the finely ground beet pulp to be described further on. For the determination of sugar a proper weight of the cossettes or pulp obtained as described above, taken after thorough mixing, is placed in a flask graduated properly and treated with water.[180]
The flask in which the mixture takes place should be marked to compensate for the volume of the fiber of the cane. When the normal weight of cane is taken for the ventzke scale, viz., 26.048, the flask should be graduated at 102.6 cubic centimeters. If double the normal weight be taken, the flask should be graduated at 205.2 cubic centimeters. This graduation is based on the assumption of the presence of fiber amounting to ten per cent of the weight of the cossettes. The fiber is so nearly the density of the juice obtained as to be regarded as one gram equal to one cubic centimeter. The flask is at first filled almost full of water and then warmed to near the boiling point for an hour with frequent shaking. It is then filled to a little above the mark, the contents well mixed and warmed for ten minutes more with frequent shaking. After cooling, the volume is made up to the mark, well shaken and poured upon a filter. The filtrate is collected in a sugar flask marked at fifty and fifty-five cubic centimeters. When filled to the first mark a proper quantity of lead subacetate is added, the volume completed to the second mark with water, the contents of the flask well shaken, poured upon a filter and the filtrate polarized in the usual way.
The reducing sugar is determined in an aliquot part of the filtrate by one of the alkaline copper methods.
213. Determination by Drying and Extraction.—Instead of the diffusion and polarization method just described, the fine pulp obtained may be dried, the dried residue ground in a drug mill and extracted with aqueous alcohol or with water.
To facilitate the calculation when this method is employed, the water content of a small portion of the well sampled pulp is determined. The rest of the pulp is dried, first for a few hours at a temperature not [Pg 239] above 60° or 70°, and then at the temperature of boiling water, either in the open air or a partial vacuum, until all the water is driven off. The dried residue can then be preserved in well stoppered bottles for the determination of sugar at any convenient period. The finely ground dried residue for this purpose is placed in an extraction apparatus and thoroughly exhausted with eighty per cent alcohol. The extract is dried and weighed, giving the total weight of all sugars present. After weighing, the extract is dissolved in water, made up to a definite volume and the reducing sugars determined in an aliquot portion thereof by the usual methods. The weight of reducing sugars found, calculated for the whole extract deducted from the total weight of this extract will give the weight of the sucrose in the sample. From this number the content of sugar in the original cane is determined from the percentage of water found in the original sample.
Example.—In a sample of finely pulped canes the content of water is found to be 76.5 per cent. The thoroughly dried pulp is ground and extracted with aqueous alcohol. Five grams give two and five-tenths grams of the extract. The extract is dissolved in water, made up to a definite volume and the reducing sugars determined in an aliquot part and calculated for the whole, amounting to 150 milligrams. The extract is therefore composed of 2.35 grams of sucrose and 0.15 gram of reducing sugars. The calculation is now made to the original sample which contained 76.5 per cent of water and 23.5 per cent of dry matter, as follows:
5 : x :: 23.5 : 100, whence x = 21.27,
the weight of the original material corresponding to five grams of the dry substance. The original composition of the sample is therefore expressed by the following numbers:
| Per cent. | |
| Sucrose | 11.1 |
| Reducing sugars | 0.7 |
| Water | 76.5 |
| Fiber (insoluble matter) | 11.7 |
214. Examination of the Bagasse.—The method just described for [Pg 240] the examination of canes may be also applied to the analysis of bagasses, with the changes made necessary by the increased percentage of fiber therein. On account of the large surface exposed by the bagasse, the sampling, shredding and weighing should be accomplished as speedily as possible to avoid loss of moisture.
The optical examination of bagasses is rendered difficult by reason of the uneven pressure to which the canes are subjected. With fairly good milling in technical work the bagasses will have at least thirty per cent of fiber. The method for the polariscopic examination is therefore based upon that assumption, but the volume of the solution must be changed for varying percentages of fiber in the bagasse. On account of the smaller percentage of sugar, it is convenient to take double or three times the normal weight of the bagasse for examination. Since large sugar flasks are not commonly to be had the diffusion of the bagasse may be conducted in a quarter liter flask. In a quarter liter flask place 52.096 grams of the finely shredded bagasse, very nearly fill the flask with water and extract the sugar as described for canes in the foregoing paragraphs. In the weight of bagasse used there will be, in round numbers, fifteen grams of fiber. When the volume of water is completed to the mark the actual content of liquid in the flask will therefore be only 235 cubic centimeters. Fifty cubic centimeters of the filtrate are placed in a sugar flask marked at fifty and fifty-five cubic centimeters, the proper quantity of lead subacetate solution added, the volume completed to the upper mark, the contents of the flask well shaken, filtered and polarized in a 200 millimeter tube. Let the reading obtained be four degrees and increase this by one-tenth for the increased volume of solution above fifty cubic centimeters. The true reading is therefore four degrees and four-tenths. This reading, however, must be corrected, because the original volume instead of being 200 cubic centimeters, is 235 cubic centimeters. The actual percentage of sugar in the sample examined is obtained by the following proportion:
200 : 235 = 4.4 : x.
The correct reading is therefore 5°.2, the percentage of sugar in the sample examined. [Pg 241]
The results obtained by the method just described may vary somewhat from the true percentage by reason of the variation of the content of fiber in the bagasse. It is, however, sufficiently accurate for technical control in sugar factories and on account of its rapidity of execution is to be preferred for this purpose. More accurate results would be obtained by drying the bagasse, and proceeding with the examination in a manner entirely analogous to that described for the extraction of sugar from dried canes by aqueous alcohol. In both instances the reducing sugar is determined in the manner already mentioned.
215. Determination of Fiber in Cane.—In estimating the content of sugar in canes by the analysis of the expressed juices, it is important to make frequent determinations of the fiber for the purpose of obtaining correct data for calculation. In periods of excessive drought, or when the canes are quite mature, the relative content of fiber is increased, while, on the other hand, in case of immature canes, or during excessive rainfalls, it is diminished. The chief difficulty in determining the content of fiber in canes is found in securing a representative sample. On account of the hard and fibrous nature of the envelope and of their nodular tissues, canes are reduced to a fine pulp with great difficulty by the apparatus in ordinary use. A fairly homogeneous pulp, however, may be obtained by means of the shredder described on page 9. The canes having been shredded as finely as possible, a weighed quantity is placed in any convenient extraction apparatus and thoroughly exhausted with hot water. The treatment with hot water should be continued until a few drops of the extract evaporated on a watch glass will leave no sensible residue. The residual fiber is dried to constant weight at the temperature of boiling water, cooled in a desiccator and rapidly weighed and the percentage of fiber calculated from the data obtained. On account of the great difficulty of securing a homogeneous pulp, even with the best shredding machines, the determination should be made in duplicate or triplicate and the mean of the results entered as the percentage of fiber. The term fiber as used in this sense, must not be confounded with the same term employed in the analysis of fodders and feeding [Pg 242] stuffs. In the latter case the term is applied to the residue left after the successive treatment of the material with boiling, dilute acid and alkali. The analysis of canes for feeding purposes is conducted in the general manner hereinafter described for fodders.
216. Estimation of Sugar in Sugar Beets.—The methods employed for the determination of the sugar content of beets are analogous to those used for canes, with such variations in the method of extraction as are made possible and necessary by the difference in the nature of these sacchariferous plants. The sugar beet is more free of fiber and the hard and knotty substances composing the joints of plants are entirely absent from their composition. For this reason they are readily reduced to a fine pulp, from which the sugar is easily extracted. The analytical processes are also greatly simplified by the complete absence of reducing sugars from the juices of healthy beets. The only sugar aside from sucrose which is present in these juices is raffinose, and this is not found in healthy beets, except when they have been injured by frost or long keeping. In practical work, therefore, the determination of sucrose completes the analysis in so far as sugars are concerned. Four methods of procedure will illustrate all the principles of the various processes employed.
217. Estimation of Sucrose in the Expressed Juice.—In the first method the beets are reduced by any good shredding machine, to a fine pulp, which is placed in a press and the juice expressed. In this liquor, after clarification with lead subacetate, the sucrose is determined by the polariscope. The methods of measuring, clarifying and polarizing are the same as those described for saccharine juices in paragraphs 83-85. The mean percentage of juice in the sugar beet is ninety-five. The corrected polariscopic reading obtained multiplied by 0.95 will give the percentage of sugar in the beet.
Example.—The solids in a sample of beet juice, as measured by a brix spindle, are 17.5 per cent. Double the normal weight of the juice is measured from a sucrose pipette, placed in a sugar flask, clarified, the volume completed to 100 cubic centimeters, the contents of the flask well shaken and filtered. The polariscopic reading obtained is 29°.0. Then (29.0 ÷ 2) × 0.95 = 13.8 = percentage of sucrose in the beet. [Pg 243]
218. Instantaneous Diffusion.—In the second process employed for determining the sugar content of beets, the principle involved depends on the use of a pulp so finely divided as to permit of the almost instant diffusion of the sugar present throughout the added liquid. This diffusion takes place even in the cold and the process thus presents a convenient and rapid method for the accurate determination of the percentage of sugar in beets. The pulping is accomplished by means of the machine described on page 10, or the one shown in Fig. 67. The beet is pressed against the rapidly revolving rasp by means of the grooved movable block and the finely divided pulp is received in the box below. These machines afford a pulp which is impalpable and which readily permits an almost instantaneous diffusion of its sugar content.

Fig 67. Apparatus for Pulping Beets.
219. Pellet’s Method of Cold Diffusion.—The impalpable pulp having been obtained, by one of the processes described, the content of sugar therein is determined as follows:[181]
A normal or double normal quantity of the pulp is quickly weighed, to [Pg 244] avoid evaporation, in a sugar dish with an appropriate lip, and washed into the flask, which should be graduated, as shown in Fig. 68, to allow for the volume of the fiber or marc of the beet. Since the beet pulp contains, on an average, four per cent of marc, the volume which is occupied thereby is assumed to be a little more than one cubic centimeter. Since it is advisable to have as large a volume of water as convenient, it is the practice of Pellet to wash the pulp into a flask graduated at 201.35 cubic centimeters. If a 200 cubic centimeter flask be used, the weight of the pulp should be 25.87 instead of 26.048 grams. After the pulp is washed into the flask, about six cubic centimeters of lead subacetate of 30° baumé are added, together with a little ether, to remove the foam. The flask is now gently shaken and water added to the mark and the contents thoroughly shaken. If the pulp is practically perfect, the filtration and polarization may follow immediately. The filter into which the contents of the flask are poured should be large enough to hold the whole quantity. It is recommended to add a drop or two of strong acetic acid just before completing the volume of the liquid in the flask to the mark. The polarization should be made in a 400 millimeter tube, which will give directly the percentage of sugar present. It is not necessary to heat the solution in order to insure complete diffusion, but the temperature at which the operation is conducted should be the ordinary one of the laboratory. In case the pulp is not as fine as should be, the flask should be allowed to stand for half an hour after filling, before filtration. An insufficient amount of lead subacetate may permit some rotatory bodies other than sugar to pass into solution, and care should be taken to have always the proper quantity of clarifying material added. The presence of these rotating bodies, mostly of a pectic nature, may be shown by extracting the pulp first with cold water until all the sugar is removed, and afterwards with boiling water. The liquor obtained from the last precipitation will show a decided right-handed rotation, unless first treated with lead subacetate, in which case the polarization will be zero. A very extended experience with the instantaneous cold aqueous diffusion has shown that the results obtained thereby are quite as reliable as those given by hot alcoholic or aqueous digestion.
[Pg 245] 220. Flask for Cold Diffusion and Alcohol Digestion.—For convenience in washing the pulp into the sugar flask, the latter is made with an enlarged mouth as shown in Fig. 68. The dish holding the weighed quantity of pulp is held with the lip in the mouth of the flask, and the pulp washed in by means of a jet of water furnished from a pressure bottle or washing flask. The flask shown is graduated for the normal weight of pulp, viz., 26.048 grams. The marking is on the constricted neck and extends from 100 to 101.3 cubic centimeters. This permits of making the proper allowance for the volume occupied by the marc or fiber, but this is unnecessary for the usual character of control analyses. In the case of healthy, fresh beets, the volume occupied by the marc is nearly one and three-tenths cubic centimeters for the normal polariscopic weight of 26.048 grams of pulp. For the laurent instrument this volume is nearly one cubic centimeter.

Figure 68. Apparatus for Cold Diffusion.
221. Extraction with Alcohol.—The third method of determining sugar in beets is by alcoholic extraction. The principle of the method is based on the fact that aqueous alcohol of not more than eighty per [Pg 246] cent strength will extract all the sugar from the pulp, but will not dissolve the pectic and other rotatory bodies, which, in solution, are capable of disturbing the rotatory power of the sugar present. It is also further to be observed that the rotatory power of pure sucrose, in an aqueous alcoholic solution, is not sensibly different from that which is observed in a purely aqueous liquid. The pulp, which is to be extracted, should be in as fine a state of subdivision as convenient, and the process may be carried on in any of the forms of extraction apparatus already described, or in the apparatus shown in Fig. 69. The extraction tube, of the ordinary forms of apparatus, however, is scarcely large enough to hold the required amount of pulp, and therefore special tubes and forms of apparatus have been devised for this method of procedure. In weighing the pulp for extraction, a quarter, half, or the exact amount required for the polariscope employed, should be used. If the tubes are of sufficient size the full weight may be taken, viz., 26.048 or 16.19 grams for the instruments in ordinary use. Since the pulp contains a large quantity of water, the extraction could be commenced with alcohol of standard strength, viz., about ninety-five per cent. The volume of alcohol employed should be such as will secure a strength of from seventy to eighty per cent when mixed with the water contained in the pulp. The flask receiving the extract should be kept in continuous ebullition and the process may be regarded as complete in about one hour, when the pulp has been properly prepared. The method of extracting beet pulp with alcohol is due to Scheibler, and in its present form the process is conducted according to the methods described by Scheibler, Sickel, and Soxhlet.[182]

Fig. 69. Sickel-Soxhlet Extractor.
If the pulp be obtained by any other means than that of a fine rasp, the extraction of the sugar by the aqueous alcohol takes a long time, and even a second extraction may be necessary. It is convenient to use as a flask for holding the solvent, one already graduated at 100 or 110 cubic centimeters. A flask especially constructed for this purpose, has a constricted neck on which the graduations are made, and a wide mouth serving to attach it to the extracting apparatus, as shown in Fig. 68. When the extract is obtained in this way, it is not necessary to transfer it to a new flask before preparing it for polarization. When [Pg 247] the extraction is complete, the source of heat is removed, and when all the alcohol is collected in the flask, the latter is removed from the extraction apparatus, cooled to room temperature, a sufficient quantity of lead subacetate added, the flask well shaken, the volume completed to the mark with water, again well shaken and the contents of the flask thrown upon the filter. It is important to avoid loss of alcohol during filtration. For this purpose it is best to have a folded filter and to cover the funnel immediately after pouring the contents of the flask upon the filter paper, with a second larger funnel. The stem of the [Pg 248] funnel carrying the filter paper, should dip well into the flask receiving the filtrate. As in other cases of filtering sugar juices for polarization, the first portions of the filtrate received should be rejected. The percentage of sugar is obtained in the filtrate in the usual way.
Where a weight of pulp equal to the normal factor of the polariscope employed is used, and the extract collected in a 100 cubic centimeter flask, the percentage of sugar is directly obtained by making the reading in a 200 millimeter tube. With other weights of pulp, or other sizes of flask, the length of the observation tube may be changed or the reading obtained corrected by multiplication or division by an appropriate factor. A battery of sickel-soxhlet extractors is shown in Fig. 69.[183]

Fig. 70.
222. Scheibler’s Extraction Tube.—In order to secure a speedy extraction of large quantities of pulp, Scheibler recommends the use of the extraction tube shown in Fig. 70.[184] The apparatus is composed of three concentric glass cylinders. The outer and middle cylinders are sealed together at the top, and the inner one is movable and carries a perforated diaphragm below, for filtering purposes. Near the top it is provided with small circular openings, whereby the alcoholic vapors may gain access to the condenser (not shown). The middle cylinder is provided with two series of apertures, through the higher of which the vapor of alcohol passes to the condenser, while the alcohol which has passed through the pulp and collected between the inner and middle cylinders, flows back through the lower into the flask (not shown) containing the boiling alcohol.
The middle cylinder is provided with a curved bottom to prevent the filtering end of the inner tube from resting too tightly against it.
The tube containing the pulp is thus protected from the direct heat of the alcoholic vapors during the progress of extraction by a thin cushion of liquid alcohol.
223. Alcoholic Digestion.—The fourth method of determining sugar in beet pulp, is by means of digestion with hot alcohol. The [Pg 249] principle of this method is precisely the same as that which is involved in aqueous diffusion in the cold. The diffusion, however, in the case of the alcohol, is not instantaneous, but is secured by maintaining the mixture of the pulp and alcohol for some time at or near the boiling point. The methods of preparing the pulp, weighing it and introducing it into the digestion flask are precisely those used for aqueous digestion, but in the present case a somewhat coarser pulp may be employed. The method is commonly known as the rapp-degener process.[185]
Any convenient method of heating the alcohol may be used. In this laboratory the flasks are held on a false bottom in a bath composed of two parts of glycerol and one of water. One side of the bath holder is made of glass, as shown in Fig. 71, in order to keep the flasks in view. In order to avoid the loss of alcohol, the digestion flask should be provided with a reflux condenser, or be attached to an ordinary condenser, which will reduce the vapors of alcohol again to a liquid. Unless the weather be very warm, the reflux condenser may consist of a glass tube of rather wide bore and at least one meter in length, as shown in Fig. 71. A slight loss of alcohol during the digestion is of little consequence. A convenient method of procedure is the following.
Double the quantity of the beet pulp required for the ventzke polariscope, viz., 52.096 grams, weighed in a lipped metal dish, is washed, by means of alcohol, into a flask marked at 202.6 cubic centimeters, and the flask filled two-thirds with ninety-five per cent alcohol and well shaken. Afterwards, a proper quantity of lead subacetate is added, and then sufficient alcohol to complete the volume to the mark. The flask is then attached to the condenser, placed in a water-glycerol bath and heated to a temperature of 75° for about forty-five minutes. At the end of this time, the flask is removed from the bath and condenser, cooled quickly with water, alcohol added to the mark and well shaken. The filtration should be accomplished with precautions, to avoid the loss of alcohol mentioned in paragraph 221. The filtrate is examined in the polariscope in a 200 millimeter tube, and the reading obtained gives directly the percentage of sugar in the sample examined. Half the quantity of pulp mentioned, in a 101.3 cubic centimeter flask, may also be used. A convenient form [Pg 250] of arranging a battery of flasks is shown in the accompanying figure.

Fig. 71. Battery for Alcoholic Digestion.
224. Determination of Sugar in Mother Beets.—In selecting mother beets for seed production, it is necessary to secure only those of a high sugar content. This is accomplished by boring a hole about two and a half centimeters in diameter obliquely through the beet by means of the apparatus shown in Fig. 72.
The beet is not injured for seed production by this process, and the pulp obtained is used for the determination of sugar. The juice is expressed by means of the small hand press shown in Fig. 73. Since only a small quantity of juice is obtained, it is advisable to prepare it for polarization in a sugar flask marked at fifty cubic centimeters. The density of the juice, by reason of its small volume, is easiest [Pg 251] obtained by the hydrostatic balance, as described in paragraph 53. In lieu of this, the juice may be quickly weighed in a counterbalanced dish on a balance giving results accurate to within one milligram. The rest of the analytical process is similar to that already described.

Fig. 72. Rasp for Sampling Mother Beets.

Fig. 73. Hand Press for Beet Analysis.

Fig. 74.
225. Aqueous Diffusion.—The process of instantaneous aqueous diffusion may also be applied to the examination of mother beets. For [Pg 252] this purpose the beets are perforated by a rasp, devised by Keil, shown lying on the floor in Fig. 72, the characteristics of which are shown in Fig. 74. The conical end of the rasp is roughened in such a way as to reduce the beet to an impalpable pulp. This end is fastened by a bayonet fastening to the cylindrical carrier or arm in such a way that, by means of a groove in the conical end of the rasp, the pulp is introduced into the cylinder. The cylinder is provided with a small piston by means of which the pulp can be withdrawn when the cylindrical portion of the rasp is detached from the driving machinery. It is important that the rasp be driven at a high rate of speed, viz., from 1500 to 2000 revolutions a minute. The sample of pulp at this rate of revolution is taken almost instantly, and with skilled manipulators the whole operation of taking a sample, removing the rasp by means of its bayonet fastenings, withdrawing the sample of pulp and replacing the rasp ready for another operation does not consume more than from ten to twenty seconds. From three to four samples may thus be taken in a minute. The samples of pulp as taken are dropped into numbered dishes corresponding to the numbers on the beets. One-quarter of the normal weight for the polariscope is used for the analysis. The pulp is placed in a fifty cubic centimeter flask, water and lead subacetate added, the flask well shaken, filled to the mark with water, again well shaken, the contents thrown on the filter, and the filtrate polarized in a 400 millimeter tube, giving the direct percentage of sugar. For practical purposes the percentage of marc in the beet may be neglected. If the polarization take place in a 200 millimeter tube the number obtained should be multiplied by two for the content of sugar.
In numbering sugar beets which are to be analyzed for seed production, it is found that a small perforated tin tag bearing a number may be safely affixed to the beet by means of a tack. It is not safe to use paper tags as they may become illegible by becoming wet before the [Pg 253] sorting of the beets is completed. Where from 1000 to 2000 beets are to be examined in a day, the number of the beets and the dishes corresponding thereto must be carefully controlled to avoid confusion and mistakes.
226. Determination of Sugars without Weighing.—An ingenious device for the rapid analysis of mother beets is based upon the use of a machine which cuts from the beet a core of given dimensions and this core is subsequently reduced to a pulp which is treated with cold water and polarized in the manner described above. The cutting knives of the sampler can be adjusted to take a core of any desired size. Since the beets used for analysis have essentially the same specific gravity, the cores thus taken weigh sensibly the same and the whole core is used for the analysis, thus doing away with the necessity of weighing. The core obtained is reduced to a pulp in a small machine so adjusted as to permit the whole of the pulp, when prepared, to be washed directly into the sugar flask. By the use of this machine a very large number of analyses can be made in a single day, and this is highly important in the selection of mother beets, for often 50,000 or 100,000 analyses are to be made in a short time.

Fig. 75. Tube for Continuous Observation.
227. Continuous Diffusion Tube.—To avoid the delay occasioned by filling and emptying observation tubes in polariscopic work, where large numbers of analyses of canes and beets are to be made, Pellet has devised a continuous diffusion tube, by means of which a solution, which has just been observed, is rapidly and completely displaced by a fresh solution. This tube, improved by Spencer, is shown in Fig. 75. The fresh solution is poured in at the funnel, displacing completely the [Pg 254] old solution which flows out through the tube at the other end. The observer watches the field vision and is able to tell when the old solution is completely displaced by the clearing of the field, at which time the reading of the new solution can be quickly made. When solutions are all ready for examination an expert observer can easily read, by the aid of this device, from four to five of them in a minute.
228. Analysis of Sirups and Massecuites.—The general principles which control the analysis of sirups and massecuites are the same whether these products be derived from canes or beets. In the case of the products of canes, the sirups or massecuites contain chiefly sucrose, invert sugar, and other copper reducing bodies, inorganic matters and water. In the case of products derived from sugar beets the contents are chiefly sucrose, inorganic matters, a trace of invert sugar, raffinose and water. The principles of the determination of these various constituents have already been described.
229. Specific Gravity.—The specific gravity of sirups and molasses can be determined by the spindle in the usual way, but in the case of molasses which is quite dense, the spindle method is not reliable. It is better, therefore, both in molasses and massecuites, to determine the density by dilution. For this purpose, as described by Spencer, a definite weight of material, from 200 to 250 grams, is dissolved in water and the volume of the solution completed to half a liter. A portion of the solution is then placed in a cylinder and the quantity of total solids contained therein determined in the usual way by a brix or specific gravity hydrometer. In case 250 grams of the material be used the calculation of the brix degree for the original material is conducted according to the following formula:
| x = | G × B × V |
| W |
In the above formula x is the required brix degree, V the volume of the solution, B the observed brix degree of the solution, and G the corresponding specific gravity obtained from the table on page 73. When only small quantities of the material are at hand the hydrostatic balance (53) should be employed. For this [Pg 255] purpose twenty-five grams of the material are dissolved in water and the volume of the solution made up to 100 cubic centimeters. The sinker of the hydrostatic balance is placed in the solution and equilibrium secured by placing the weights upon the arm of the balance in the usual manner. Since the arm of the balance is graduated to give, by direct reading, the specific gravity, the density can be obtained at once.
Example.—Let the position of the weights or riders upon the balance arm be as follows:
| (1) at point of suspension of the bob | = 1.000 |
| (3) at mark 7 on beam | = 0.07 |
| (4) at mark 9 on beam | = 0.009 |
| Specific gravity | = 1.079 |
The nearest brix degree corresponding to this specific gravity (58) is 19. The total weight of the solution is equal to 100 × 1.079, viz., 107.9 grams. Since the solution contains nineteen per cent of solid matter as determined by the hydrostatic balance, the total weight of solid matter therein is 107.9 × 19 ÷ 100 = 20.5 grams. The total per cent. of solid matter in the original sample is therefore 20.5 ÷ 25 × 100 = 82 and the specific gravity corresponding thereto (page 74) is 1.42934.
The specific gravity of a massecuite may also be determined in pyknometers especially constructed for this purpose.[186]
230. Determination Of Water.—The accurate determination of water in sirups and massecuites is a matter of considerable difficulty. The principles of conducting the process (26), applicable also to the determination of water in honeys and other viscous liquids, are as follows: In all cases where invert sugar is present the drying should be conducted at a temperature not exceeding 75° or 80°. In dense molasses and massecuites a weighed quantity should be dissolved and made up to a definite volume and an aliquot portion taken for the determination. In order to secure complete desiccation at a low temperature, the drying should be accomplished in partial vacuum (pages 22, 23). The process of desiccation should be conducted in shallow, flat-bottom dishes which may be conveniently and cheaply made of aluminum and the process is hastened by filling the dish previously [Pg 256] with thoroughly dried fragments of pumice stone. When the sample does not contain any invert sugar the desiccation can be safely accomplished at the temperature of boiling water. Drying should be continued in all cases until practically constant weight is obtained.
231. Determination Of Ash.—Ash is an important constituent of the sirups, molasses, and massecuites from canes and exists in very much larger quantities in the same products from beets. The ash may be determined directly by careful incineration, but it is customary to add a few drops of sulfuric acid, sufficient to combine with all the bases present and be in slight excess. The presence of sulfuric acid is of some advantage in the beginning of the carbonization and renders the process somewhat easier of accomplishment. When sulfuric acid is used, the weight of ash obtained must be diminished by one-tenth to allow for the increased weight obtained by the conversion of the carbonates into sulfates. In general, the principles and methods described on pages 36-40 are to be employed.
232. Determination of Reducing Sugars in Sirups, Molasses, and Massecuites.—The quantity of reducing sugars in the products derived from the sugar beet, as a rule, is insignificant. In the products from sugar cane there are large quantities of reducing matters which, in general, are determined by any of the standard methods already given. It has been shown by the author[187] that the juices of healthy sugar canes contain a small quantity of invert sugar, but this statement has been contradicted by Bloufret.[188] It is certain, however, that the reducing bodies derived from the products of manufacture of sugar cane and sorghum deport themselves in a manner somewhat different from pure invert sugar. In the absence of definite information in respect of the constitution of these bodies, the methods applicable to dextrose and invert sugar may be applied.
Since the paragraphs relating to these processes were printed some important improvements in the preparation of the alkaline copper solutions have been made. The copper carbonate solution, as has already been said, is peculiarly suited to the determination of reducing sugars in the presence of sucrose and the modified forms of this solution, and [Pg 257] the methods of employing them with invert sugar, dextrose, levulose, and maltose, are described below.
233. Estimation of Minute Quantities of Invert Sugar in Mixtures.—The method of Hiller and Meissl, paragraph 142, may be used for the estimation of small quantities of invert sugar in mixtures. A modified form of Soldaini’s reagent is, however, to be preferred for this purpose. Ost has proposed and tested a copper carbonate solution for the purpose mentioned which gives reliable results.[189] The solution has the following composition:
| One liter contains | 3.6 | grams | crystallized copper sulfate. |
| 250.0 | ” | potassium carbonate. | |
| 100.0 | ” | hydrogen potassium sulfate. |
This reagent undergoes no change when kept for a long while, especially in large vessels. Even in smaller vessels it can be kept for a year or more without undergoing any change.
The method of analysis is the same as that described in paragraph 128, with the exception that the boiling is continued for only five minutes instead of ten, and the quantities of the copper and sugar solutions used are doubled, being 100 and fifty cubic centimeters respectively. In no case must the solution used contain more than thirty-eight milligrams of invert sugar. The quantity of sucrose in the mixture is obtained by polarization (94). Ost has also recalculated the reduction values of the common sugars for the strong copper carbonate solution, and the numbers obtained are slightly different from those given on page 142.[190]
For different percentages of invert sugar in mixtures of sucrose, the quantities of invert sugar are calculated from the number of milligrams of copper obtained by the following table: [Pg 258]
| Milligrams of Invert Sugar in Mixtures of | ||||||||
|---|---|---|---|---|---|---|---|---|
| 5(C) | 2(C) | 1.5(C) | 1.0(C) | 0.8(C) | 0.6(C) | 0.5(C) | ||
| (A) | (B) | 95(D) | 98(D) | 98.5(D) | 99.0(D) | 99.2(D) | 99.4(D) | 99.5(D) |
| 88 | 37.9 | 37.1 | 36.0 | 35.4 | 34.7 | 34.2 | 33.9 | 33.6 |
| 85 | 36.3 | 35.5 | 34.5 | 34.0 | 33.4 | 32.9 | 32.5 | 32.2 |
| 80 | 33.9 | 33.0 | 33.2 | 31.7 | 31.2 | 30.7 | 30.2 | 29.9 |
| 75 | 31.6 | 30.7 | 30.0 | 29.5 | 29.0 | 28.5 | 28.1 | 27.7 |
| 70 | 29.4 | 28.5 | 27.8 | 27.4 | 26.8 | 26.4 | 25.9 | 25.6 |
| 65 | 27.3 | 26.3 | 25.7 | 25.3 | 24.7 | 24.3 | 23.8 | 23.5 |
| 60 | 25.2 | 24.2 | 23.6 | 23.2 | 22.6 | 22.2 | 21.8 | 21.5 |
| 55 | 23.1 | 22.1 | 21.6 | 21.2 | 20.6 | 20.2 | 19.8 | 19.6 |
| 50 | 21.2 | 20.1 | 19.6 | 19.2 | 18.6 | 18.3 | 17.9 | 17.7 |
| 45 | 19.3 | 18.2 | 17.6 | 17.2 | 16.7 | 16.3 | 16.0 | 15.8 |
| 40 | 17.3 | 16.3 | 15.7 | 15.3 | 14.8 | 14.5 | 14.2 | 14.0 |
| 35 | 15.4 | 14.5 | 13.8 | 13.4 | 13.0 | 12.7 | 12.5 | 12.3 |
| 30 | 13.5 | 12.6 | 12.0 | 11.6 | 11.2 | 11.0 | 10.8 | 10.6 |
| 25 | 11.5 | 10.8 | 10.3 | 10.0 | 9.5 | 9.3 | 9.1 | 9.0 |
| 20 | 9.6 | 9.1 | 8.6 | 8.3 | 7.9 | 7.7 | 7.5 | 7.3 |
| 15 | 7.7 | 7.3 | 6.9 | 6.7 | 6.3 | 6.1 | 5.8 | 5.6 |
| 10 | 5.8 | 5.4 | 5.1 | 5.0 | 4.7 | 4.5 | 4.2 | 3.9 |
| Milligrams of Invert Sugar in Mixtures of | ||||||
|---|---|---|---|---|---|---|
| 0.4(C) | 0.3(C) | 0.2(C) | 0.1(C) | 0.05(C) | 0.02(C) | |
| (A) | 99.6(D) | 99.7(D) | 99.8(D) | 99.9(D) | 99.95(D) | 99.98(D) |
| 88 | 33.3 | |||||
| 85 | 32.0 | 31.8 | ||||
| 80 | 29.7 | 29.5 | ||||
| 75 | 27.4 | 27.2 | ||||
| 70 | 25.3 | 25.0 | ||||
| 65 | 23.2 | 22.8 | ||||
| 60 | 21.2 | 20.8 | 20.4 | |||
| 55 | 19.3 | 18.9 | 18.5 | |||
| 50 | 17.4 | 17.0 | 16.7 | |||
| 45 | 15.6 | 15.3 | 14.9 | |||
| 40 | 13.8 | 13.5 | 13.2 | |||
| 35 | 12.1 | 11.9 | 11.5 | 10.3 | ||
| 30 | 10.4 | 10.2 | 9.9 | 8.8 | ||
| 25 | 8.8 | 8.6 | 8.2 | 7.3 | ||
| 20 | 7.1 | 6.9 | 6.6 | 5.8 | 4.9 | |
| 15 | 5.4 | 5.2 | 5.0 | 4.4 | 3.7 | 2.0 |
| 10 | 3.8 | 3.5 | 3.4 | 3.0 | 2.5 | 1.7 |
234. Soldaini’s Method Adapted to Gravimetric Work.—By reason of their better keeping qualities and because of their less energetic action on non-reducing sugars, copper carbonate solutions are to be preferred to the alkaline copper tartrate solutions for gravimetric determinations of reducing sugars in cane juices and sugar house products, provided the difficulties which attend the manipulation can be removed. Ost has succeeded in securing perfectly satisfactory results with copper carbonate solution by slightly varying the composition thereof and continuing the boiling, for the reduction of the copper, ten minutes.[191] The copper solution is made as follows:
| 17.5 | grams | crystallized copper sulfate. |
| 250.0 | ” | potassium carbonate. |
| 100.0 | ” | ”bicarbonate. |
The above ingredients are dissolved in water and the volume of the solution completed to one liter. The object of the potassium bicarbonate [Pg 259] is to secure in the solution an excess of carbon dioxid and thus prevent the deposition of basic copper carbonate on keeping. The manipulation is conducted as follows:
One hundred cubic centimeters of the copper solution are mixed with half that quantity of the sugar solution in a large erlenmeyer, which is placed upon a wire gauze, heated quickly to boiling and kept in ebullition just ten minutes. The sugar solution should contain not less than eighty nor more than 150 milligrams of the reducing sugar, and the quantity of the solution representing this should be diluted to fifty cubic centimeters before mixing with the copper solution. After boiling, the contents of the erlenmeyer are quickly cooled and filtered with suction through an asbestos filter and the whole of the copper suboxid washed into the filter tube. This precipitated suboxid is washed once with a little potassium carbonate solution then with hot water and finally with alcohol, well dried, heated to redness, and the copper oxid obtained reduced to metallic copper in an atmosphere of hydrogen entirely free of arsenic. From the weight of metallic copper obtained the quantity of sugar which has been oxidized is calculated from the tables below.
It is evident that the process given above may be varied so as to conform to the practice observed in this laboratory of cooling the boiling solution sufficiently at once by adding to it an equal volume of recently boiled, cold water, collecting the precipitated copper suboxid in a gooch, and, after washing it, securing solution in nitric acid and the precipitation of the copper by electrolysis. [Pg 260]
Table Showing Milligrams Dextrose,
Levulose and Invert Sugar Oxidized,
Corresponding to Milligrams of
Copper Reduced.
Corresponding Table for Maltose.
| Milligrams copper obtained. |
Milligrams maltose anhydrid oxidized. |
Milligrams maltose hydrate oxidized. |
|---|---|---|
| 435 | 263.7 | 277.6 |
| 430 | 259.3 | 273.0 |
| 425 | 255.0 | 268.4 |
| 420 | 250.9 | 264.1 |
| 415 | 247.0 | 260.0 |
| 410 | 243.2 | 256.0 |
| 405 | 339.4 | 252.0 |
| 400 | 235.6 | 248.0 |
| 395 | 231.9 | 244.1 |
| 390 | 228.2 | 240.2 |
| 385 | 224.6 | 236.4 |
| 380 | 221.1 | 232.7 |
| 375 | 217.7 | 229.1 |
| 370 | 214.4 | 225.6 |
| 365 | 211.1 | 222.2 |
| 360 | 207.9 | 218.8 |
| 355 | 204.7 | 215.4 |
| 350 | 201.5 | 212.1 |
| 345 | 198.3 | 208.7 |
| 340 | 195.2 | 205.4 |
| 335 | 192.0 | 202.1 |
| 330 | 188.8 | 198.8 |
| 325 | 185.7 | 195.4 |
| 320 | 182.5 | 192.1 |
| 315 | 179.4 | 188.8 |
| 310 | 176.3 | 185.6 |
| 305 | 173.3 | 182.4 |
| 300 | 170.3 | 179.2 |
| 295 | 167.3 | 176.1 |
| 290 | 164.4 | 173.0 |
| 285 | 161.4 | 169.9 |
| 280 | 158.5 | 166.8 |
| 275 | 155.5 | 163.7 |
| 270 | 152.6 | 160.7 |
| 265 | 149.7 | 157.6 |
| 260 | 146.8 | 154.6 |
| 255 | 143.9 | 151.5 |
| 250 | 141.1 | 148.5 |
| 245 | 138.2 | 145.5 |
| 240 | 135.4 | 142.5 |
| 235 | 132.5 | 139.5 |
| 230 | 129.7 | 136.5 |
| 225 | 126.8 | 133.5 |
| 220 | 124.0 | 130.6 |
| 215 | 121.2 | 127.6 |
| 210 | 118.4 | 124.7 |
| 205 | 115.7 | 121.8 |
| 200 | 112.9 | 118.9 |
| 195 | 110.2 | 116.0 |
| 190 | 107.4 | 113.1 |
| 185 | 104.7 | 110.2 |
| 180 | 101.9 | 107.3 |
| 175 | 99.2 | 104.4 |
| 170 | 96.4 | 101.5 |
| 165 | 93.7 | 98.6 |
| 160 | 90.9 | 95.7 |
| 155 | 88.2 | 92.8 |
| 150 | 85.4 | 89.9 |
| 145 | 82.6 | 87.0 |
| 140 | 79.9 | 84.1 |
| 135 | 77.1 | 81.2 |
| 130 | 74.4 | 78.3 |
| 125 | 71.6 | 75.4 |
| 120 | 68.9 | 72.5 |
| 115 | 66.1 | 69.6 |
| 110 | 63.4 | 66.7 |
| 105 | 60.6 | 63.8 |
| 100 | 57.9 | 60.9 |
| 95 | 55.1 | 58.0 |
| 90 | 52.3 | 55.1 |
| 85 | 49.6 | 52.2 |
| 80 | 46.8 | 59.3 |
| 75 | 44.1 | 56.4 |
| 70 | 41.4 | 53.5 |
[Pg 262] 235. Weighing the Copper as Oxid.—In the usual methods of the determination of reducing bodies, the percentage is calculated either volumetrically from the quantity of the sugar solution required to decolorize a given volume of the alkaline copper solution, or the reduced copper suboxid is brought into a metallic state by heating in an atmosphere of hydrogen or by electrolytic deposition. A quicker method of procedure is found in completing the oxidation of the cupric oxid by heating to low redness in a current of air.[192] For this determination the precipitation of the cuprous oxid and its filtration are made in the usual manner. The cuprous oxid is collected in a filtering tube, made by drawing out to proper dimensions a piece of combustion tube, and has a length of about twelve centimeters in all. The unchanged part of the tube is about eight centimeters in length and twelve millimeters in diameter. It is filled by first putting in a plug of glass wool and covering this with an asbestos felt on top of which another plug of glass wool is placed. After the cuprous oxid is collected in the tube it is washed with boiling water, alcohol and ether. The rubber tube connecting it with the suction is of sufficient length to permit the tube being taken in one hand and brought into a horizontal position over a bunsen. The tube is gradually heated, rotating it meanwhile, until any residual moisture, alcohol or ether, is driven off from the filtering material. The layer of glass wool holding the cuprous oxid is gradually brought into the flame and as the oxidation begins the material will be seen to glow. The heating is continued for some time after the glowing has ceased, in all for three or four minutes, the tube and the copper oxid which it contains being brought to a low redness. The current of air passing over the red-hot material in this time oxidizes it completely. The filtering tube, before use, must be ignited and weighed in exactly the same manner as described above. The heat is so applied as not to endanger the rubber tube attached to one end of the filtering tube nor to burn the fingers of the operator as he turns the tube during the heating. After complete oxidation the tube is cooled in a desiccator and weighed, the increase of weight giving the copper oxid. For the atomic weights, 63.3 copper [Pg 263] and 15.96 oxygen, one gram of copper oxid is equivalent to 0.79864 gram of copper, and for the weights 63.17 copper and 15.96 oxygen, one gram of copper oxid equals 0.79831 gram of copper. From the amount of metallic copper calculated by one of these factors, the reducing sugar is determined by the tables already given.
236. Estimation of Dry Substance, Polarization and Apparent Purity for Factory Control.—For technical purposes the methods of determining the above factors, proposed by Weisberg and applicable to concentrated sirups, massecuites, and molasses, may be used.[193] Five times the half normal quantity of the material, viz., 65.12 grams, are placed in a quarter liter flask, dissolved in water and the flask filled to the mark. In the well shaken mixture, which is allowed to stand long enough to be free of air, the degree brix is estimated by an accurate spindle. For example, in the case of molasses, let the number obtained be 18.8.
Fifty cubic centimeters of the solution are poured into a 100 cubic centimeter flask, the proper quantity of lead subacetate added, the flask filled to the mark with water, its contents filtered, and the filtrate polarized in a 200 millimeter tube. Let the number obtained on polarization be 22°.1. This number may be used in two ways. If it be multiplied by two the polarization of the original sample is obtained; in this case, viz., 44°.2. In the second place, if 44.2 be multiplied by 0.26048 and this product divided by the specific gravity corresponding to 18°.8. viz., 1.078, the quotient 10.68 is secured representing the polarization or per cent of sugar contained in the solution of which the degree brix was 18.8°. From the numbers 18.8 and 10.68 the apparent purity of the solution, 56.8, is calculated, viz., 10.68 × 100 ÷ by 18.8. The original product as calculated above gives a polarization of 44.2 and this number multiplied by 100 and divided by 56.8 gives 77.8, or the apparent percentage of dry matter. The original sample of molasses, therefore, had the following composition:
| Degree brix (total solids) | 77.8 | per cent. |
| Sucrose | 44.2 | ” |
| Solids, not sucrose | 33.6 | ” |
| Apparent purity | 56.8 | ” |
[Pg 264] It is seen from the above that with a single weighing and a single polarization, and within from ten to fifteen minutes, all needful data in respect of the proper treatment of molasses for the practical control and direction of a factory can be obtained.
In case a laurent polariscope is used, five times the normal weight, viz., eighty-one grams of the raw material are used and the process conducted as above.
237. Occurrence.—Sucrose and invert sugar are found together in many commercial products, especially in raw sugars and molasses made from sugar cane, and in these products sucrose is usually predominant. They also form the principal saccharine contents of honey, the invert sugar, in this case, being the chief ingredient.
In commercial grape sugar, made from starch, dextrose is the important constituent, while in the hydrolysis of starch by a diastatic ferment, maltose is principally produced. In the manufacture of commercial glucose by the saccharification of starch with sulfuric acid, dextrin, maltose, and dextrose are the dominant products, while in the similar substance midzu ame, maltose and dextrose are chiefly found, and only a small quantity of dextrose.[194] In honeys derived from the exudations of coniferous trees are found also polarizing bodies not enumerated above and presumably of a pentose character.[195] In evaporated milks are usually found large quantities of sucrose in addition to the natural sugar therein contained. These mixtures of carbohydrates often present problems of great difficulty to the analyst, and the following paragraphs will be devoted to an elucidation of the best approved methods of solving them.
238. Sucrose and Invert Sugar.—The chemical methods of procedure to be followed in the case of a sample containing both sucrose and invert sugar have been given in sufficient detail in preceding paragraphs (124, 171). [Pg 265] When, however, it is desirable to study further the composition of the mixture, important changes in the method are rendered imperative. While the estimation of the sucrose and the total invert sugar, or the sum of the dextrose and levulose, is easy of accomplishment the separate determination of the dextrose and levulose is not so readily secured. In the latter case the total quantity of the two sugars may be determined, and after the destruction or removal of one of them the other be estimated in the usual way; or in the mixture the levulose can be determined by the variation in its gyrodynat, caused by changes of temperature.
239. Optical Neutrality of Invert Sugar.—The gyrodynat of levulose decreases as the temperature rises (107) and at or near a temperature of 87°.2, it becomes equal to that of dextrose, and, therefore, pure invert sugar composed of equal molecules of levulose and dextrose is optically neutral to polarized light at that temperature. On this fact Chandler and Ricketts have based a method of analysis which excludes any interference in polarization due to invert sugar.[196] To secure the polarization at approximately a temperature of 87°, a water-bath is placed between the nicols of an ordinary polariscope in such a way as to hold a tubulated observation tube in the optical axis of the instrument. The ends of the bath, in the prolongation of this axis, are provided with clear glass disks. The space between the cover glasses of the observation tube and the glass disks of the bath is occupied by the water of the bath. When this is kept at a constant temperature it does not interfere with the reading. The observation tube may be of glass, but preferably is constructed of metal plated with platinum on the inside. For the most exact work the length of the observation tube, at 87°, is determined by measurement or calculation. The bath is heated with alcohol lamps or other convenient means. The arrangement of the apparatus is shown in Fig. 75.
In a mixture of sucrose and invert sugar any rotation of the plane of polarized light at 87° is due to the sucrose alone. In a mixture of dextrose and sucrose the polarization is determined, and, after inversion, again determined at 87°. The latter number is due to dextrose alone, and the difference between the two gives the rotation due to sucrose. [Pg 266]

Fig. 75.—Chandler and Ricketts’ Polariscope.
240. Sucrose and Raffinose.—In raw sugars made from beet molasses considerable quantities of raffinose are found. The method of inversion and polarization in such cases is described in paragraph 100. In making the inversion by the method proposed by Lindet (95), and conducting the polarization on a laurent instrument, a slightly different formula, given below, is used; viz.:
| S = | C - 0.4891A |
| 0.810 | |
| and R = | A - S |
| 1.54 | |
[Pg 267] in which the several letters refer to the same factors as are indicated by them in the formula of Creydt. In the application of the formula just given the normal weight of the mixed raw sugars used is 16.2 grams.[197]
241. Optical Determination of Levulose.—The determination of levulose by optical methods alone is made possible by reason of the fact that the gyrodynats of the sugars with which it is associated are not sensibly affected by changes of temperature. The principle of the process, as developed by the author, rests on the ascertainment of the change in the gyrodynat of levulose when its rotation is observed at widely separated temperatures.[198] The observation tube employed for reading at low temperatures is provided with desiccating end tubes, which prevent the deposition of moisture on the cover glasses. The relations of this device to the optical parts of the apparatus are illustrated in Fig. 76.

Fig. 76.—Apparatus for Polarimetric Observations
at Low Temperatures.
The protecting tubes are made of hard rubber and the desiccation is secured by surrounding the space between the rubber and the perforated metal axis with fragments of potash or calcium chlorid.
The details of the construction are shown in a horizontal section through the center of the observation tube in Fig. 77. In this figure [Pg 268] the observation tube, made of glass or metal, is represented by i, the metal jacket, open at the top in the V shape as described, by k. The observation tube is closed by the heavy disk b made of non-polarizing glass. This disk is pressed against the end of the observation tube by the rubber washer a, when the drying system about to be described is screwed on to k. The apparatus for keeping the cover glass dry is contained in the hard rubber tube m and consists of a perforated cylinder of brass e, supported at one end by the perforated disk c and at the outer ends by the arms d. It is closed by a cover glass of non-polarizing glass s and can be screwed on to the system h at n. The space p is filled with coarse fragments of caustic soda, potash, or calcium chlorid by removing the cover glass s. The perforated disk c prevents any of the fragments from entering the axis of observation. When the cover glass s is replaced, it just touches the free end of the perforated metal tube preventing any of the fragments of the drying material from falling into the center at the outer end. When this drying tube is placed in position, the contents of the observation tube i can be kept at the temperature of zero for an indefinite time without the deposition of a particle of moisture either upon the glass b or s.

Fig. 77.—Construction of Desicating Tube.
[Pg 269] For determining the rotation at a high temperature the apparatus of Chandler and Ricketts (238) may be used or the following device: The polarizing apparatus shown above, Fig. 76, may be used after the V shape box is removed from the stand, which is so constructed as to receive a large box covered with asbestos felt an inch thick. The observation tube is held within this box in the same way as in the one just described so that the hot water extends not only the entire length of the tube but also covers the cover glasses. In both cases the cover glasses are made of heavier glass and are much larger in diameter than found in the ordinary tubes for polariscopes. The protecting cylinders of hard rubber are not needed at high temperatures but can be left on without detriment.
The illustration, Fig. 78, shows the arrangement of the apparatus with a silver tube in position, which can be filled and emptied without removing it.

Fig. 78.—Apparatus for Polarizing
at High Temperatures.
In practice the water is heated with a jet of steam and an even temperature is secured by a mechanical stirrer kept slowly in motion. [Pg 270] With such a box it is easy to maintain a temperature for several hours which will not vary more than half a degree. The temperature for reading the hot solutions was fixed at 88°, this being nearly the temperature at which a mixture of equal molecules of levulose and dextrose is optically inactive. In every case the sugar solutions were made up to the standard volume at the temperatures at which they were to be read and thus the variations due to expansion or contraction were avoided. When solutions are read at a high temperature, they must be made with freshly boiled water so as to avoid the evolution of air bubbles which may otherwise obscure the field of vision.
By means of the apparatus described it is easy for the analyst to make a polarimetric reading at any temperature desired. In all cases the observation tube should be left at least a half an hour and sometimes longer in contact with the temperature control media before the reading is made.
The appearance of the field of vision is usually a pretty fair index of the point of time at which a constant temperature is established throughout all parts of the system. Any variation in temperature produces a distortion of the field of vision while a constant fixed temperature will disclose the field of vision in its true shape and distinctness of outline.
Principles of the Calculation.—If 26.048 grams of pure sucrose be dissolved in water and the volume made 100 cubic centimeters, it will produce an angular rotation of 34°.68 when examined in a 200 millimeter tube with polarized sodium monochromatic light. Upon the cane sugar scale of an accurately graduated shadow instrument the reading will be 100 divisions corresponding to 100 per cent of pure sucrose.
In the complete inversion of the cane sugar the reaction which takes place is represented by the following formula:
| — | + | ||
| C₁₂H₂₂O₁₁ + | H₂0 = | C₆H₁₂O₆ + | C₆H₁₂O₆. |
The minus and plus signs indicate that the resulting invert sugar is a mixture of equal parts of levulose (d fructose) and dextrose (d glucose). We are not concerned here with the fact that a complete inversion of cane sugar is a matter of great difficulty nor [Pg 271] with the danger which is always experienced of destroying a part of one of the products of inversion. They are matters which may cause a variation in the analytical data afterward, but do not affect the principles on which the process is based.
In the inversion of 26.048 grams of cane sugar there are therefore produced 13.71 grams of levulose and 13.71 grams of dextrose or, in all, 27.42 grams of the mixed sugars.
The angular rotation which would be produced by 13.71 grams of dextrose in a volume of 100 cubic centimeters and through a column 200 millimeters in length is, with sodium light, 14°.53 equivalent to 41.89 divisions of the cane sugar scale. The specific rotatory power of a dextrose solution of the density given is almost exactly 53, and this number is used in the calculations.
In a mixture of the two sugars under the conditions mentioned and at a temperature of 0° the angular rotation observed is -15°.15 equivalent to 43.37 divisions of the cane sugar scale.
The + rotation due to the dextrose is 14°.53. Therefore the total negative rotation due to levulose at 0° is 15°.15 + 14°.53 = 29°.68. Hence the gyrodynat of levulose at 0° and in the degree of concentration noted is readily calculated from the formula
| [α]°D = - | 29.68 × 100 | = -108.24. |
| 2 × 13.71 |
Since at 88° (circa) the mixture of levulose and dextrose is neutral to polarized light, it follows that at that temperature the specific rotatory power of levulose is equal to that of dextrose, viz., 53°.
[α]D⁸⁸ ° = - 53°.
The total variation in the specific rotatory power of levulose, between zero and 88°, is 55°.24. The variation for each degree of temperature, therefore, of the specific rotatory power of levulose is equal to 55.24 divided by 88, which is equal to 0.628. From these data it is easy to calculate the specific rotatory power of levulose for any given temperature. For instance, let it be required to determine the [Pg 272] gyrodynat of levulose at a temperature of 20°. It will be found equal to 108.24 - 0.628 × 20 = 95.68. The required rotatory power is then [a]²⁰ °D = -95°.68.
In these calculations the influence of the presence of hydrochloric acid upon the rotatory power of the levulose is neglected.
Since the variation in angular rotation in the mixture at different temperatures is due almost wholly to the change in this property of the levulose it follows that the variation for each degree of temperature and each per cent of levulose can be calculated. Careful experiments have shown that the variation in the rotatory power of levulose between 0° and 88° is represented by a straight line. For 13.71 grams per 100 cubic centimeters the variation for each degree of temperature is equal to 43.37 ÷ 88 = 0.49 divisions on the cane sugar scale, or 15.15 ÷ 88 = 0°.1722 angular measure. If 13.71 grams of levulose in 100 cubic centimeters produce the deviations mentioned for each degree of temperature, one gram would give the deviation obtained by the following calculations:
For the cane sugar scale 0.49 ÷ 13.71 = 0°.0357 and for angular rotation 0.1722 ÷ 13.71 = 0.01256.
The above data afford a simple formula for calculating the percentage of levulose present from the variation observed in polarizing a solution containing levulose, provided that the quantity of levulose present is approximately fourteen grams per 100 cubic centimeters.
Example.—Suppose in a given case the difference of reading between a solution containing an unknown quantity of levulose at 0° and 88° is equal to thirty divisions of the cane sugar scale. What weight of levulose is present? We have already seen that one gram in 100 cubic centimeters produces a variation of 0.0357 division for 1°. For 88° this would amount to 3.1416 divisions. The total weight of levulose present is therefore 30 ÷ 3.1416 = 9.549 grams. In the case given 26.048 grams of honey were taken for the examination. The percentage of levulose was therefore 9.549 × 100 ÷ 26.048 = 36.66 per cent.
If it be inconvenient to determine the polarimetric observations at [Pg 273] temperatures so widely separated as 0° and 88° the interval may be made less. In the above case if the readings had been made at 20° and 70° the total variation would have been only ⁵⁰/⁸⁸ of the one given, viz., 17.05 divisions of the cane sugar scale. The calculation would then have proceeded as follows:
0.0357 × 50 = 1.785.
Then, 17.05 ÷ 1.785 = 9.552 grams of levulose, from which the actual percentage of levulose can be calculated as above.
With honeys the operation is to be conducted as follows:
Since honeys contain approximately twenty per cent of water and in the dry substance have approximately forty-five per cent of levulose, about 38.50 grams of the honey should be taken to get approximately 13.8 grams of levulose.
In the actual determination the calculations may be based on the factors above noted, but without respect to the degree of concentration. If half the quantity of dextrose noted be present its specific rotatory power is only reduced to about 52°.75, and this will make but little difference in the results. In the case of honey 13.024 grams of the sample are conveniently used in the examination, half the normal weight for the ventzke sugar scale. The error, however, due to difference in concentration is quite compensated for by the ease of clarification and manipulation. Alumina cream alone is used in the clarification, thus avoiding the danger of heating the solution to a high temperature in the presence of an excess of lead acetate.
An interesting fact is observed in cooling solutions of honey to 0°. The maximum left hand rotation is not reached as soon as the temperature reaches 0° but only after it has been kept at that temperature for two or three hours. The line representing the change in rotatory power in solutions of honey between 10° and 88° is practically straight but from 10° to 0°, if measured by the readings taken without delay, it is decidedly curved; the reading being less at first than it is afterwards. After three hours the 0° becomes sensibly constant and then the whole line is nearly straight, but still with a slight deficiency in the reading at the 0°. For this reason the computations should be based on readings between 10° and 88° rather than on a number [Pg 274] covering the whole range of temperature. Nevertheless, if the solution be kept at 10° for three hours before the final reading is taken, no error of any practical magnitude is introduced.
The calculations given above, for the cane sugar scale, can also be made in an exactly similar manner for angular rotation. The angular variation produced by one gram of levulose for 1° of temperature is 0°.01256. For 88° this would become 1°.10528. Suppose the total observed angular deviation in a given case between 0° and 88° to be 10°.404, then the weight of levulose present is 10.404 ÷ 1.10528 = 9.413 grams.
In the case mentioned 26.048 grams of honey were taken for the examination. The percentage of levulose present, therefore, was 9.413 × 100 ÷ 26.048 = 36.13.
241. General Formula for the Calculation of Percentage of Levulose.—Let K = deviation in divisions of the cane sugar scale or in angular rotation produced by one gram of levulose for 1° temperature.
Let T and tʹ = temperatures at which observations are made.
Let R = observed deviation in rotation.
Let W = weight of levulose obtained.
Let L = per cent of levulose required.
| Then L = | R | ÷ W. |
| K(T - tʹ) |
In most genuine honeys the value of R between 0° and 88° is approximately thirty divisions of the cane sugar scale or 10° angular measure for 26.048 grams in 100 cubic centimeters, read in a 200 millimeter tube, or, for 13.024 grams in 100 cubic centimeters read in a 400 millimeter tube.
The method of analysis outlined above has been applied in the examination of a large number of honeys with most satisfactory results. It can also be applied with equal facility to other substances containing levulose.
242. Sucrose and Dextrose.—In mixtures these two sugars are easily determined by optical processes, provided no other bodies sensibly affecting the plane of polarized light be present. The total [Pg 275] deviation due to both sugars is determined in the usual way. The percentage of sucrose is afterwards found by the inversion method (92). The rotation, in the first instance due to the sucrose, is calculated from the amount of this body found by inversion, and the residual rotation is caused by the dextrose. The percentage of dextrose is easily calculated by a simple proportion into which the numbers expressing the gyrodynats of sucrose and dextrose enter. When the readings are made on a ventzke scale the calculations are made as follows:
| Weight of sample used | 26.048 | grams. |
| First polarization | 88°.5 | |
| Polarization after inversion | 10°.5 | |
| Temperature | 20°.0 | |
| Percentage of sucrose | 58.4 | |
| Rotation due to dextrose | 30°.1 |
Percentage of dextrose:
66.5 : 53 = x : 30.1; whence x = 37.8.
The sample examined therefore contains 58.4 per cent of sucrose and 37.8 per cent of dextrose.
It is evident that the method just described is also applicable when maltose, dextrin, or any other sugar or polarizing body, not sensibly affected by the process of inversion to which the sucrose is subjected, is substituted for dextrose. When, however, more than two optically active bodies are present the purely polariscopic process is not applicable. In such cases the chemical or the combined chemical and optical methods described further on can be employed.
243. Lactose in Milk.—By reason of its definite gyrodynat lactose in milk is quickly and accurately determined by optical methods, when proper clarifying reagents are used to free the fluid of fat and nitrogenous substances. Soluble albuminoids have definite levogyratory powers and, if not entirely removed, serve to diminish the rotation due to the lactose.
Milk casein precipitated by magnesium sulfate has the following gyrodynatic numbers assigned to it:[199]
| Dissolved | in | water [a]D = -80° |
| ” | ” | very dilute solution [a]D = -87°. |
| ” | ” | dilute sodium hydroxid solution [a]D = -76°. |
| ” | ” | strong potassium hydroxid solution [a]D = -91°. |
[Pg 276] The hydrates of albumen have rotation powers which vary from [a]D = -71°.40 to [a]D = -79°-05. From the chaotic state of knowledge concerning the specific rotating power of the various albumens, it is impossible to assign any number which will bear the test of criticism. For the present, however, this number may be fixed at [a]D = -70° for the albumens which remain in solution in the liquids polarized for milk sugar.[200]
Many reagents have been prepared for the removal of the disturbing bodies from milk in order to make its polarization possible. Among the precipitants which have been used in this laboratory may be mentioned:[201]
(1) Saturated solution basic lead acetate, specific gravity 1.97:
(2) Nitric acid solution of mercuric nitrate diluted with an equal volume of water: (88.)
(3) Acetic acid, specific gravity 1.040, containing twenty-nine per cent acetic acid:
(4) Nitric acid, specific gravity 1.197, containing thirty per cent nitric acid:
(5) Sulfuric acid, specific gravity 1.255, containing thirty-one per cent sulfuric acid:
(6) Saturated solution of sodium chlorid:
(7) Saturated solution of magnesium sulfate:
(8) Solution of mercuric iodid in acetic acid, formula; potassium iodid, 33.2 grams; mercuric chlorid, 13.5 grams; strong acetic acid, 20.0 cubic centimeters; water 640 cubic centimeters.
Alcohol, ether, and many solutions of mineral salts, hydrochloric and other acids are also used as precipitants for albumen, but none of them presents any advantages.
Experience has shown that the best results in polariscopic work are secured by the use of either the mercuric iodid or the acid mercuric nitrate for clarifying the milk. The latter reagent should be used in quantities of about three cubic centimeters for each 100 of milk. It is evident when it is desired to determine the residual nitrogen in solution, the former reagent must be employed. The quantity of albuminoid matter left in solution after clarification with mercurial salts is so minute as to exert no sensible effect on the rotation of the plane of polarized light produced by the lactose. [Pg 277]
For purposes of calculation the gyrodynat of lactose in the ordinary conditions of temperature and concentration may be represented by [a]D = 52°.5 (107).
Polarization.—The proper weight of milk is placed in a sugar flask, diluted with water, clarified with the mercuric salt, the volume completed to the mark, and the contents shaken and poured on a filter. The filtrate is polarized in tubes of convenient length. The observed rotation may be expressed either in degrees of angular measurement or of the sugar scale. The weight of milk used may be two or three times that of the normal weight calculated for the instrument employed. Instead of weighing the milk a corresponding volume determined by its specific gravity may be delivered from a burette-pipette (p. 231). For the laurent polariscope three times, and for the half-shadow instruments for lamplight, twice the normal weight of milk should be used. For approximately sixty cubic centimeters of milk the flask should be marked at 105 cubic centimeters in compensation for the volume of precipitated solids or the reading obtained from a 100 cubic centimeter flask, decreased by one-twentieth.
For the laurent instrument the normal weight of lactose is determined by the following proportions:
Gyrodynat of sucrose, 66.5: lactose: 52.5 = x: 16.19.
Whence x = 20.51, that is, the number of grams of pure lactose in 100 cubic centimeters required to read 100 divisions of the sugar scale of the instrument.
For the ventzke scale the normal quantity of lactose required to read 100 divisions is found from the following equation:
66.4 : 52.5 = x : 26.048
Whence x = 32.74.
In the one case three times the normal weight of milk is 61.53 and in the other twice the normal weight, 65.48 grams.
244. Error due to Volume of Precipitate.—Vieth states that the volume allowed for the precipitated solids in the original process, viz., two and four-tenths cubic centimeters, is not sufficiently large.[202] In such cases it is quite difficult to decide on any arbitrary correction based on the supposed quantities of fat and [Pg 278] albuminoids present. A better method than to try to compensate for any arbitrary volume is to remove entirely the disturbing cause or eliminate it by indirect means. To wash the precipitate free of sugar without increasing the bulk of the filtrate unduly would be extremely difficult and tend, moreover, to bring some of the precipitated matters again into solution. It is better, therefore, to eliminate the error by double dilution and polarization (86). The principle of this method is based on the fact, that, within limits not sensibly affecting the gyrodynat by reason of different densities, the polarizations of two solutions of the same substance are inversely proportional to their volumes.
For convenience, it is recommended that the volumes of the samples in each instance be 100 and 200 cubic centimeters, respectively, in which case the true reading is obtained by the simple formula given in the latter part of 86.
In this laboratory the double dilution method of determining the volume of the precipitate is conducted as follows:[203]
In each of two flasks marked at 100 and 200 cubic centimeters, respectively, are placed 65.52 grams of milk, four cubic centimeters of mercuric nitrate added, the volume completed to the mark and the contents of the flask well shaken.
After filtering, the polarization is made in a 400 millimeter tube by means of the triple shadow polariscope described in 75. From the reading thus obtained the volume of the precipitate and the degree of correction to be applied are calculated as in the subjoined example. The flasks should be filled at near the temperature at which the polarizations are made and the observation room must be kept at practically a constant temperature of 20° to avoid the complications which would be produced by changes in the gyrodynat of lactose and the value of the quartz plates and wedges of the apparatus by marked variations in temperature.
Example.—Weight of milk used in each case 65.52 grams.
| Polarimetric | reading | from | the | 100 | cubic | centimeter | flask, | 20°.84 |
| ” | ” | ” | ” | 200 | ” | ” | ” | 10°.15 |
[Pg 279] which is the corrected reading showing the percentage of lactose in the sample used.
The volume of the precipitate is calculated as follows:
20.84 ÷ 4 = 5.21, the apparent percentage of lactose present.
Then 5.21 : 4.94 = 100 : x.
Whence x = 94.82. From this number it is seen that the true volume of the milk solution polarized is 94.82 instead of 100 cubic centimeters, whence the volume occupied by the precipitate is 100 - 94.82 = 5.18 cubic centimeters. So little time is required to conduct the analysis by the double dilution method as to render it preferable in all cases where incontestable data are desired. Where arbitrary corrections are made the volume allowed for the precipitate may vary from two and a half cubic centimeters in milks poor in fat, to six for those with a high cream content.
For milks of average composition sufficient accuracy is secured by making an arbitrary correction of five cubic centimeters for the volume of the precipitate.
245. Conditions of Separation.—In the foregoing paragraphs the optical methods for determining certain sugars have been described. Many cases arise, however, in which these processes are inapplicable or insufficient. In these instances, the analyst, as a rule, will be able to solve the problem presented by the purely chemical methods which have been previously described, or by a combination of the chemical and optical processes. Not only have the different sugars distinctive relations to polarized light, but also they are oxidized by varying quantities of metallic salts and these differences are sufficiently pronounced to secure in nearly every instance, no matter how complex, data of a high degree of accuracy.
The carbohydrates of chief importance, from an agricultural point of view, are starch and sucrose; while the alternation products of chief importance, derived therefrom by chemical and biological means, are dextrin, maltose, dextrose and invert sugar. [Pg 280]
246. Sucrose, Levulose, and Dextrose.—The purely chemical methods of separating these three sugars have been investigated by Wiechmann.[204] They are based on the data obtained by determining the percentage of reducing sugars, both before and after the inversion of the sucrose, and before and after the removal of the levulose. For the destruction of the levulose, the method of Sieben is employed, and attention is called to the fact that the complete removal of the levulose by this process is difficult of accomplishment, and is probably attended with alterations of the other sugars present.
247. Sieben’s Method of Determining Levulose.—The decomposing action of hot hydrochloric acid on levulose, and its comparative inaction on dextrose are the basis of Sieben’s process.[205] The hydrochloric acid employed should contain about 220 grams of the pure gas per liter, that is, be of twenty-two per cent strength, corresponding to 1.108 specific gravity. If the substance acted on be invert sugar, its solution should be approximately of two and a half per cent strength. To 100 cubic centimeters of such a solution, sixty of the hydrochloric acid are added, and the mixture immersed in boiling water for three hours.
After quickly cooling, the acid is neutralized with sodium hydrate of thirty-six times normal strength. Ten cubic centimeters of the hydrate solution will thus neutralize the sixty of hydrochloric acid which have been used to destroy the levulose. The work of Wiechmann discloses the fact, easily prevised, that the method used for destroying levulose is not always effective and that action of the reagent is not exclusively confined to the levogyrate constituent of the mixture. Nevertheless, data of reasonable accuracy may be secured by this process, which is best carried out as described by Wiechmann. In this connection the possibility of the polymerization of the dextrose molecules, when heated with hydrochloric acid, must not be overlooked.
248. The Analytical Process.—The total quantity of invert sugar in a given solution is determined by the methods already given (136, 141.) [Pg 281]
After this has been accomplished, the levulose is destroyed as described above, and the dextrose determined by any approved method (136, 140). In the presence of sucrose, the sum of the reducing sugars is first determined as in 136, 142. After the inversion of the sucrose, the invert sugar is again determined, and the increased quantity found, calculated to sucrose. The levulose is then destroyed by hydrochloric acid, and the dextrose determined as described above. The quantity of sucrose may also be determined by an optical method (91, 92, 94.).
249. Calculation of Results.—If we represent by a the weight of metallic copper reduced by the invert sugar present in a solution containing sucrose, and by b that obtained after the inversion of the sucrose, the quantity of copper corresponding to the sucrose is b - a = c. After the destruction of the levulose, the copper reduced by the residual dextrose may be represented by d. The weight of copper equivalent to the levulose is, therefore, b - d = e. From the tables already given, the corresponding quantities of the sugars equivalent to c, d, and e are directly taken. Example:
| a = | 300 | milligrams | = | 163.8 | milligrams | invert sugar. | |
| 156.5 | ” | dextrose. | |||||
| 185.63 | ” | levulose. | |||||
| b = | 500 | ” | |||||
| d = | 275 | ” | = | 142.8 | ” | dextrose. | |
| c = | 200 | ” | = | 106.3 | ” | invert sugar. | |
| e = | 225 | ” | = | 133.89 | ” | levulose. | |
The 106.3 milligrams of invert sugar equivalent to c, correspond to 101 milligrams of sucrose. The quantity of dextrose equivalent to 275 milligrams of copper is 142.8. Of this amount 53.15 milligrams are due to the inverted sucrose, leaving 89.65 milligrams arising from the invert sugar and dextrose originally present. This quantity is equivalent to 175 milligrams of copper.
Of the 300 milligrams of copper obtained in the first instance, 125 are due to levulose in the original sample, corresponding to 69.73 milligrams which number, multiplied by two, gives the invert sugar present.
The sample examined, therefore, had the following composition:
| Sucrose | 101.00 | milligrams. |
| Invert sugar | 139.46 | ” |
| Dextrose | 19.92 | ” |
| Sum | 260.38 | ” |
On the other hand, if the invert sugar be calculated from the quantity corresponding to the 225 milligrams of copper corresponding to e, the data will be very different from those given above. In this instance of the levulose found corresponding to 225 milligrams of copper, viz., 133.89, 53.15 milligrams are due to the inverted sucrose. Then the quantity due to the invert sugar at first present is 133.89 - 53.15 = 80.74 milligrams. Since half the weight of invert sugar is levulose, the total weight of the invert sugar at first present is 161.48, leaving only 8.91 milligrams due to added dextrose. The difficulties in these calculations doubtless arise from the imperfect destruction of the levulose, and from variations in the reducing action of sugars on copper salts in the presence of such large quantities of sodium chlorid.
250. Calculation from Data obtained with Copper Carbonate.—The wide variations observed in different methods of calculations in the preceding paragraph, are due in part to the different degrees of oxidation exerted on alkaline copper tartrate by the dextrose and levulose. Better results are obtained by conducting the analytical work with Ost’s modification of Soldaini’s solution (128).
The relative quantities of levulose and dextrose oxidized by this solution are almost identical, and the calculations, therefore, result in nearly the same data, whether made from the numbers obtained with the residual dextrose or from the levulose destroyed. The method of applying this method is illustrated in the following calculation.
Example.—In a mixture of sucrose, invert sugar, and dextrose, the quantities of copper obtained by using the copper carbonate solution were as follows: [Pg 283]
| Copper | obtained | before | inversion | = a = | 150 | milligrams. |
| ” | ” | after | ” | = b = | 250 | ” |
| ” | ” | ” | destroying lev’e | = d = | 137.5 | ” |
| ” | equivalent | to | inverted sucrose | = b - a = c = | 100 | ” |
| ” | ” | ” | levulose | = b - d = e = | 112.5 | ” |
| a = | 150 | milligrams | Cu | = | 44.0 | milligrams | invert sugar | |
| 45.3 | ” | dextrose | ||||||
| 42.5 | ” | levulose. | ||||||
| d = | 137.5 | ” | ” | = | 41.55 | ” | dextrose. | |
| c = | 100 | ” | ” | = | 29.5 | ” | invert sugar | |
| = 28.025 | sucrose. | |||||||
| e = | 112.5 | ” | ” | = | 31.9 | ” | levulose. | |
| 14.75 | milligrams | of | dextrose = | 48.5 | milligrams | Cu. |
| 14.75 | ” | ” | levulose = | 51.5 | ” | ” |
137.5 - 48.5 = 89.0 milligrams Cu due to dextrose present before inversion.
| 150.0 - | 89.0 | milligrams | Cu | = 27 | milligrams | dextrose before inversion. |
| 89.0 | ” | ” | = 61.0 | ” | Cu due to levulose present before inversion. | |
| 61.0 | ” | ” | = 17.8 | ” | levulose before inversion. |
| 17.8 × 2 = | 35.6 | milligrams | invert sugar | present | before | inversion. |
| 27.0 - 17.8 = | 9.2 | ” | dextrose | ” | ” | ” |
Again:
The respective quantities of the three sugars in the solution are, therefore:
| Sucrose | = 28.025 | milligrams. |
| Invert sugar | = 35.6 | ” |
| Dextrose | = 9.2 | ” |
The calculations made from the later data (234) give almost the same results.
251. Winter’s Process.—Winter has proposed a method of separating dextrose and levulose in the presence of sucrose based on [Pg 284] the selective precipitation produced on treating mixtures of these sugars in solution with ammoniacal lead acetate.[206]
The reagent is prepared immediately before use by adding ammonia to a solution of lead acetate until the opalescence which is at first produced just disappears. The separation is based on the fact that the compound of sucrose with the reagent is easily soluble in water, while the salts formed with levulose and dextrose are insoluble. The separation of the sugars is accomplished as follows:
The ammoniacal lead acetate is added to the solution of the mixed sugars until no further precipitate is produced. The precipitated matters are digested with a large excess of water and finally separated by filtration. The sucrose is found in the filtrate in the form of a soluble lead compound, from which it is liberated by treatment with carbon dioxid. The lead carbonate produced is separated by filtration and the sucrose is estimated in an aliquot part of the filtrate by optical or chemical methods. The precipitate containing the lead compounds of dextrose and levulose is washed free of sucrose, suspended in water and saturated with carbon dioxid. By this treatment the lead compound with dextrose is decomposed and, on filtration, the dextrose will be found in the filtrate, while the lead compound of the levulose is retained upon the filter with the lead carbonate. After well washing the precipitate, it is again suspended in water and saturated with hydrogen sulfid. By this treatment the lead levulosate compound is broken up and the levulose obtained, on subsequent filtration, in the filtrate. The dextrose and levulose, after separation as above described, may be determined in aliquot parts of their respective filtrates by the usual gravimetric methods. Before determining the levulose the solution should be heated until all excess of hydrogen sulfid is expelled.
This method was used especially by Winter in separating the various sugars obtained in the juices of sugar cane. It has not been largely adopted as a laboratory method, and on account of the time and trouble required for its conduct, is not likely to assume any very great practical importance.
252. Separation of Sugars by Lead Oxid.—In addition to the combination with the earthy bases, sugar forms well defined compounds [Pg 285] with lead oxid. One of these compounds is of such a nature as to have considerable analytical and technical value. Its composition and the method of preparing it have been pointed out by Kassner.[207]
Sucrose, under conditions to be described, forms with the lead oxid a diplumbic saccharate, which separates in spheroidal crystals, and has the composition corresponding to the formula C₁₂H₁₈O₁₁Pb₂ + 5H₂O. The precipitation takes place quantitively and should be conducted as follows:
The substance containing the sucrose, which may be molasses, sirups or concentrated juices, is diluted with enough water to make a sirup which is not too viscous. Lead oxid suspended in water is stirred into the mass in such proportion as to give about two parts of oxid to one of the sugar. The stirring is continued for some time until the oxid is thoroughly distributed throughout the mass and until it becomes thick by the commencement of the formation of the saccharate. As soon as the mass is sufficiently thickened to prevent the remaining lead oxid from settling, the stirring may be discontinued and the mixture is left for twenty-four hours, at the end of which time the sucrose has all crystallized in the form of lead saccharate. The crystals of lead saccharate can be separated by a centrifugal machine or by passing through a filter press, and are thoroughly washed with cold water, in which they are almost insoluble. The washed crystals are beaten up with water into a thick paste and the lead separated as basic carbonate by carbon dioxid. The sucrose is found in solution in the residual liquor and is concentrated and crystallized in the usual way.
Reducing sugars have a stronger affinity for the lead oxid than the sucrose, and this fact is made use of to effect a nearly complete separation when they are mixed together. In order to secure this the lead oxid is added in the first place only in sufficient quantity to combine with the reducing sugars present, the process being essentially that described above. The reducing sugars which are precipitated as lead dextrosates, lead levulosates, etc., are separated in the usual way by a centrifugal or a filter press, and the resulting liquor, which contains still nearly all the sucrose, is subjected to a second [Pg 286] precipitation by the addition of lead oxid. The second precipitation obtained is almost pure diplumbic saccharate.
In the precipitation of the sugar which is contained in the beet molasses, where only a trace or very little invert sugar is present, the sucrose is almost quantitively separated, and by the concentration of the residual liquor, potash salts are easily obtained. In this case, after the decomposition of the lead saccharate by carbon dioxid, the residual sugar solution is found entirely free of lead. Where invert sugar is present, however, in any considerable proportions, it is found to exercise a slightly soluble influence on the lead saccharate, and in this case a trace of lead may pass into solution. For technical purposes, this is afterwards separated by hydrosulfuric acid or the introduction of lime sulfid.
Lead oxid is regenerated from the basic lead carbonate obtained by heating in retorts to a little above 260°, and the carbon dioxid evolved can also be used again in the technical process.
253. Commercial Glucose and Grape Sugar.—The commercial products obtained by the hydrolysis of starch are known in the trade as glucose or grape sugar. The former term is applied to the thick sirup obtained by concentrating the products of a partial hydrolysis, while the latter is applied to the solid semi-crystalline mass, secured by continuing the hydrolyzing action until the intermediate products are almost completely changed to dextrose. In this country the starch employed is obtained almost exclusively from maize, and the hydrolyzing agent used is sulfuric acid.[208] The products of conversion in glucose are chiefly dextrins and dextrose with some maltose, and in grape sugar almost entirely dextrose. When diastase is substituted for an acid, as the hydrolytic agent, maltose is the chief product, the ferment having no power of producing dextrose. In the glucose of Japan, known as midzu ame dextrin and maltose are the chief constituents.[209]
Commercial glucose is used chiefly by confectioners for manufacturing table sirups and for adulterating honey and molasses.
Commercial grape sugar is chiefly employed by brewers as a substitute for barley and other grains. [Pg 287]
In Europe, the starch which is converted into glucose, is derived principally from potatoes. The method employed in conversion, whether an acid or diastatic action, is revealed not only by the nature of the product, but also by the composition of its ash. In the case of diastatic conversion the ash of the sample will contain only a trace of sulfates, no chlorin, and be strongly alkaline, while the product of conversion with sulfuric acid will give an ash rich in sulfates with a little lime and be less strongly alkaline.
The process of manufacture in this country consists in treating the starch, beaten to a cream with water, with sulfuric acid, usually under pressure, until the product shows no blue color with iodin. The excess of acid is removed with marble dust, the sirup separated by filtration, whitened by bleaching with sulfurous acid or by passing it through bone-black and evaporated to the proper consistence in a vacuum. The solid sugar, consisting mostly of dextrose, is made in the same manner, save that the heating with the acid is continued until the dextrin and maltose are changed into maltose. The product is either obtained in its ordinary hydrated form or by a special method of crystallization secured as bright anhydrous crystals. Solutions of dextrose, when first made, show birotation, but attain their normal gyrodynatic state on standing for twenty-four hours in the cold, or immediately on boiling.
254. Methods Of Separation.—The accurate determination of the quantities of the several optically active bodies formed in commercial glucose is not possible by any of the methods now known. Approximately accurate data may be secured by a large number of processes, and these are based chiefly on the ascertainment of the rotation and reducing power of the mixed sugars, the subsequent removal of the dextrose and maltose by fermentation or oxidation and the final polarization of the residue. The difficulties which attend these processes are alike in all cases. Fermentation may not entirely remove the reducing sugars or may act slightly on the dextrin. In like manner the oxidation of these sugars by metallic salts may not entirely decompose them, may leave an optically active residue, or may affect the optical activity of the [Pg 288] residual dextrin. The quantitive methods of separating these sugars by means of phenylhydrazin, lead salts or earthy bases have not been developed into reliable and applicable laboratory processes. At the present time the analyst must be contented with processes confessedly imperfect, but which, with proper precautions, yield data which are nearly correct. The leading methods depending on fermentation and oxidation combined with polarimetric observations will be described in the subjoined paragraphs.
255. Fermentation Method.—This process is based on the assumption that, under certain conditions, dextrose and maltose may be removed from a solution and the dextrin be left unchanged. In practice, approximately accurate results are obtained by this method, although the assumed conditions are not strictly realized. In the prosecution of this method the polarimetric reading of the mixed sugars is made, and the maltose and dextrose removed therefrom by fermentation with compressed yeast. The residual dextrins are determined by the polariscope on the assumption that their average gyrodynat is 193. In the calculation of the quantities of dextrose and maltose their gyrodynats are fixed at 53 and 138 respectively. The total quantity of reducing sugar is determined by the usual processes. The relative reducing powers of dextrose and maltose are represented by 100 and 62 respectively. The calculations are made by the following formulas:[210]
| Whence | R | = d + 0.62m | (1) |
| P | = 53d + 138m + 163dʹ | (2) | |
| Pʹ | = 193dʹ | (3) |
From these three equations the values of d, m, and dʹ are readily calculated: [Pg 289]
Example: To find d and m:
| Subtract (3) from (2) | P = | 53d + 133m + 193dʹ | |
| Pʹ = | 193dʹ | ||
| P - Pʹ = | 53d + 138m | (4) | |
| Multiply (1) by 53 and subtract from (4) | P - Pʹ = | 53d + 138m | |
| 53R = | 53d + 32.86m | ||
| P - Pʹ - | 53R = 105.14m | (5) | |
| Whence m = | P - Pʹ - 53R | (6) | |
| 105.14 | |||
d = R - 0.62m(7)
| dʹ = | Pʹ | (8) |
| 193 |
Sidersky assigns the values [a]D = 138.3 and [a]D = 194.8 to maltose and dextrin respectively in the above formulas.[211]
Illustration: In the examination of a sample 26.048 grams of midzu ame in 100 cubic centimeters were polarized in a 200 millimeter tube and the following data were obtained:
Polarization of sample in angular degrees 69°.06, which is equal to an apparent gyrodynat of 132.6:
Total reducing sugar as dextrose 33.33 per cent:
Polarization in angular degrees after fermentation 30°.84 = [a]D = 59.2.
Substituting these values in the several equations gives the following numbers:
[Pg 290] Summary: Sample of midzu ame:
| Percentage | of | dextrin | 30.67 | per | cent. |
| ” | ” | maltose | 53.01 | ” | ” |
| ” | ” | dextrose | 00.47 | ” | ” |
| ” | ” | water | 14.61 | ” | ” |
| ” | ” | ash | 00.31 | ” | ” |
| Sum | 99.07 | ” | ” | ||
| Undetermined | 0.93 | ” | ” |
For polarization the lamplight shadow polariscope employed for sugar may be used, and the degrees of the sugar (ventzke) scale converted into angular degrees by multiplying by 0.3467.
The process of fermentation is conducted as described in the paragraph given further on, relating to the determination of lactose in the presence of sucrose.
256. The Oxidation Method.—The removal of the reducing sugars may be accomplished by oxidation instead of fermentation. The process of analysis is in all respects similar to that described in the foregoing paragraph, substituting oxidation for fermentation.[212] For the oxidizing agent mercuric cyanid is preferred, and it is conveniently prepared by dissolving 120 grams of mercuric cyanid and an equal quantity of sodium hydroxid in water mixing the solutions and completing the volume to one liter. If a precipitate be formed in mixing the solutions it should be removed by filtering through asbestos. For the polarization, ten grams of the sugars in 100 cubic centimeters is a convenient quantity. Ten cubic centimeters of this solution are placed in a flask of water marked at fifty cubic centimeters, a sufficient quantity of the mercuric cyanid added to remain in slight excess after the oxidation is finished (from twenty to twenty-five cubic centimeters) and the mixture heated to the boiling point for three minutes. The alkali, after cooling, is neutralized with strong hydrochloric acid and the passing from alkalinity to acidity will be indicated by a discharge of the brown color which is produced by heating with the alkaline mercuric cyanid. The heating with the mercury salt should be conducted in a well ventilated fume chamber. [Pg 291]
The calculation of the results is conducted by means of the formulas given in the preceding paragraph. In the original paper describing this method, it was stated that its accuracy depended on the complete oxidation of the reducing sugar in a manner leaving no optically active products, and on the inactivity of the reagents used in respect to the dextrin present. These two conditions are not rigidly fulfilled, as is shown by Wilson.[213] According to his data maltose leaves an optically active residue, which gives a somewhat greater right hand rotation than is compensated for by the diminished rotation of the dextrin. Wilson, however, confesses that the dextrin used contained reducing sugars, which would not be the case had it been prepared by the process of treating it with alkaline mercuric cyanid as above indicated. Upon the whole, the oxidation of the reducing sugar by a mercury salt gives results which, while not strictly accurate, are probably as reliable as those afforded by fermentation. The author has attempted to supplant both the oxidation and fermentation methods by removing the reducing sugars with a precipitating reagent, such as phenylhydrazin, but the methods are not sufficiently developed for publication.
257. Removal of Dextrose by Copper Acetate.—Maercker first called attention to the fact that Barfoed’s reagent (one part copper acetate in fifteen parts of water, and 200 cubic centimeters of this solution mixed with five cubic centimeters of thirty-eight per cent. acetic acid) reacts readily with dextrose, while it is indifferent to maltose and dextrins. Sieben’s method of removing dextrose is based on this fact.[214] It is found that under certain conditions pure maltose does not reduce either the acidified or neutral solution of copper acetate, while dextrose or a mixture of dextrose and maltose does so readily. It is also shown that the fermentation residue under suitable conditions acts like maltose. Maltose solutions reduce the reagent after boiling four minutes while at 40°-45° they have no effect even after standing four days. The amount of copper deposited by dextrose, under the latter conditions, is found to depend to a certain extent on the amount of free acetic acid present, and as the solutions of copper acetate always contain varying quantities of acetic acid which cannot be removed without decomposition and precipitation of basic salt, the [Pg 292] use of an absolutely neutral solution is impracticable. The reagent prepared according to Barfoed’s directions is almost saturated, but a half normal solution is preferable. Sieben proposes two solutions: I, containing 15.86 grams copper and 0.56 gram acetic anhydrid per liter; II, containing 15.86 grams copper and three grams acetic anhydrid per liter. The reduction of the dextrose is secured by placing 100 cubic centimeters of the solution in a bottle, adding the sugar solution, stoppering and keeping in a water-bath at 40°-45° two or three days. An aliquot portion is then drawn off and the residual copper precipitated by boiling with forty-five cubic centimeters of the alkali solution of the fehling reagent and forty cubic centimeters of one per cent dextrose solution, filtered and weighed as usual. The results show that either solution can be used, and that standing for two days at 45° is sufficient. One hundred cubic centimeters of the copper solution are mixed with ten cubic centimeters of the sugar solution containing from two-tenths to five-tenths gram of dextrose, as this dilution gives the best results. No reduction is found to have taken place when solutions containing five-tenths gram maltose or five-tenths gram fermentation residue are used. The data can not be compiled in the form of a table similar to Allihn’s, as it is impossible to obtain a solution of uniform acidity each time, and the solution will have to be standardized by means of a known pure dextrose solution and the result obtained with the unknown sugar solution properly diluted compared with this. This method of Sieben’s has never been practiced to any extent in analytical separations and can not, therefore, be strongly recommended without additional experience.
258. Removal of Dextrin by Alcohol.—By reason of its less solubility, dextrin can be removed from a solution containing also dextrose and maltose by precipitation with alcohol. It is impracticable, however, to secure always that degree of alcoholic concentration which will cause the coagulation of all the dextrins without attacking the concomitant reducing sugars. In this laboratory it has been found impossible to prepare a dextrin by alcoholic precipitation, which did not contain bodies capable of oxidizing alkaline copper solutions. [Pg 293]
The solution containing the dextrin is brought to a sirupy consistence by evaporation and treated with about ten volumes of ninety per cent alcohol. After thorough mixing, the precipitated dextrin is collected on a filter and well washed with alcohol of the strength noted. It is then dried and weighed. If weaker solutions of dextrin are used, the alcohol must be of correspondingly greater strength. In the filtrate the residual maltose and dextrose may be separated and determined by the chemical and optical methods already described.
259. The Copper Tartrate Method.—The lactose in milk is readily estimated by the gravimetric copper method described in paragraph 143. Before the application of the process the casein and fat of the milk should be removed by an appropriate precipitant, and an aliquot part of the filtrate, diluted to contain about one per cent of milk sugar, used for the determination. The clarification is very conveniently secured by copper sulfate or acetic acid, as described in the next paragraph. A proper correction should be made for the volume occupied by the precipitate and, for general purposes, with whole milk of fair quality this volume may be assumed to be five per cent. One hundred grams of milk will give a precipitate occupying approximately five cubic centimeters. In the analytical process, to twenty cubic centimeters of milk, diluted with water to eighty, is added a ten per cent solution of acetic acid, until a clear whey is shown after standing a few minutes, when the volume is completed to 100 cubic centimeters with water, and the whole, after thorough shaking, thrown on a filter. An aliquot part of the filtrate is neutralized with sodium carbonate and used for the lactose determination. This solution contains approximately one per cent of lactose. In a convenient part of it the lactose is determined and the quantity calculated for the whole. This quantity represents the total lactose in the twenty cubic centimeters of milk used. The weight of the milk is found by multiplying twenty by its specific gravity. From this number the percentage of lactose is easily found. In this process the milk is clarified by the removal of its casein and fat. Other albuminoids [Pg 294] remain in solution and while these doubtless disturb the subsequent determination of lactose, any attempt at their removal would be equally as disadvantageous. The volume of the precipitate formed by good, whole milk when the process is conducted as above described, is about one cubic centimeter, for which a corresponding correction is readily made.
260. The Official Method.—The alkaline copper method of determining lactose, adopted by the Association of Official Agricultural Chemists, is essentially the procedure proposed by Soxhlet.[215]
Dilute twenty-five cubic centimeters of the milk, held in a half liter flask, with 400 cubic centimeters of water and add ten cubic centimeters of a solution of copper sulfate of the strength given for Soxhlet’s modification of Fehling’s solution, page 129; add about seven and a half cubic centimeters of a solution of potassium hydroxid of such strength that one volume of it is just sufficient to completely precipitate the copper as hydroxid from one volume of the solution of copper sulfate. In place of a solution of potassium hydroxid of this strength eight and a half cubic centimeters of a half normal solution of sodium hydroxid may be used. After the addition of the alkali solution the mixture must still have an acid reaction and contain copper in solution. Fill the flask to the mark, shake and filter through a dry filter.
Place fifty cubic centimeters of the mixed copper reagent in a beaker and heat to the boiling point. While boiling briskly, add 100 cubic centimeters of the lactose solution, prepared as directed above, and boil for six minutes. Filter immediately and determine the amount of copper reduced by one of the methods already given, pages 149-155. Obtain the weight of lactose equivalent to the weight of copper found from the table on page 163.
261. The Copper Cyanid Process.—It has been found by Blyth that the copper cyanid process of Gerrard gives practically the same results in the determination of sugar in milk as are obtained by optical methods.[216] The milk for this purpose is clarified, by precipitating the casein with acetic acid in the following manner: [Pg 295]
Twenty-five cubic centimeters of milk are diluted with an equal volume of distilled water, and strong acetic acid added until the casein begins to separate. The liquid is heated to boiling and, while hot, centrifugated in any convenient machine. The supernatant liquid obtained is separated by filtration and the solid matter thrown upon the filter and well washed with hot water. The filtrate and washings are cooled and completed to a volume of 100 cubic centimeters. This liquid is of about the proper dilution for use with the copper cyanid reagent. The percentage of sugar determined by this reagent agrees well with that obtained by the optical method, when no other sugars than lactose are present. If there be a notable difference in the results of the two methods other sugars must be looked for. The presence of dextrin may be determined by testing a few drops of the clear liquor with iodin, which, in the presence of dextrin, gives a reddish color. Other sugars are determined by obtaining their osazones. For this purpose the filtrate obtained as above should be concentrated until the volume is about thirty cubic centimeters. Any solid matter which separates during the evaporation is removed by filtration. The osazones are precipitated in the manner described in paragraph 147. On cooling, the almost solid crystalline mass obtained is placed on a filter, washed with a little cold water, the crystals then pressed between blotting paper and dried at a temperature of 100°. The dry osazones obtained are dissolved in boiling absolute alcohol, of which just sufficient is used to obtain complete solution. The alcoholic solution is set aside for twelve hours and the separation of a crystalline product after that time shows that dextrose or invert sugar is present. Milk sugar alone gives no precipitate but only a slight amorphous deposit. The lactosazone is precipitated by adding a little water to the hot alcoholic solution and the crystals thus obtained should be dissolved in boiling absolute alcohol and reprecipitated by the addition of water at least three times in order to secure them pure. The osazones are identified by their melting points, paragraph 172. The first part of this method does not appear to have any advantage over the optical process by double dilution (p. 278), and requires more time. [Pg 296]
262. Sugars in Evaporated Milks.—In addition to the lactose normally present in evaporated milks the analyst will, in most cases, find large quantities of sucrose. The latter sugar is added as a preservative and condiment. By reason of the ease with which sucrose is hydrolyzed, evaporated milk containing it may have also some invert sugar among its contents. A method of examination is desirable, therefore, which will secure the determination of lactose, sucrose and invert sugar in mixtures. The probability of the development of galactose and dextrose during the evaporation and conservation of the sample, is not great. The best method of conducting this work is the one developed by Bigelow and McElroy.[217] The principle on which the method is based rests on the fact that in certain conditions, easily supplied, the sucrose and invert sugar present in a sample may be entirely removed by fermentation and the residual lactose secured in an unchanged condition. The lactose is finally estimated by one of the methods already described.
The details of the process follow:
On opening a package of evaporated milk, its entire contents are transferred to a dish and well mixed. Several portions of about twenty-five grams each are placed in flasks marked at 100 cubic centimeters. To each of the flasks enough water is added to bring all the sugars into solution and normal rotation is made certain by boiling. After cooling, the contents of the flasks are clarified by mercuric iodid in acetic acid solution. The clarifying reagent is prepared by dissolving fifty-three grams of potassium iodid, twenty-two grams of mercuric chlorid, and thirty-two cubic centimeters of strongest acetic acid in water, mixing the solutions and completing the volume to one liter. The clarification is aided by the use of alumina cream (84). The flask is filled to the mark, and the contents well shaken and poured on a filter. After rejecting the first portion of the filtrate the residue is polarized in the usual manner. Two or more separate portions of the sample are dissolved in water in flasks of the size mentioned, heated to 55°, half a cake of compressed yeast added to each and the temperature kept at 55° for five hours. The residue in each flask is treated as above described, the mercuric [Pg 297] solution being added before cooling to prevent the fermentative action of the yeast, and the polarization noted.
By this treatment the sucrose is completely inverted, while the lactose is not affected. The percentage of sucrose is calculated by the formulas given in paragraph 94, using the factor 142.6. At the temperature noted the yeast exercises no fermentative, but only a diastatic action.
In each case the volume of the precipitated milk solids is determined by the double dilution method, and the proper correction made (p. 278). The lactose remaining is determined by chemical or optical methods, but it is necessary, in all cases where invert sugar is supposed to be present, to determine the total reducing sugars in the original sample as lactose. If the quantity thus determined and the amount of sucrose found as above are sufficient to produce the rotation observed in the first polarization, it is evident that no invert sugar is present. When the polarization observed is less than is equivalent to the quantity of sugar found, invert sugar is present, which tends to diminish the rotation produced by the other sugars. In this case it is necessary to remove both the sucrose and invert sugar by a process of fermentation, which will leave the lactose unchanged.
This is accomplished by conducting the fermentation in the presence of potassium fluorid, which prevents the development of the lactic ferments. For this purpose 350 grams of the evaporated milk are dissolved in water and the solution boiled to secure the normal rotation of the lactose. After cooling to 80°, the casein is thrown down by adding a solution containing about four grams of glacial phosphoric acid and keeping the temperature at 80° for about fifteen minutes. After cooling to room temperature, the volume is completed to one liter with water, well shaken and poured onto a filter. An aliquot part of the filtrate is nearly neutralized with a noted volume of potassium hydroxid. Enough water is added to make up, with the volume of potassium hydroxid used, the total space occupied by the precipitated solid, corresponding to that part of the filtrate, and if necessary, refilter. The volume occupied by the precipitated solids is easily determined by polarization and double dilution. The filtrate, [Pg 298] obtained from the process described above, is placed in portions of 100 cubic centimeters each in 200 cubic centimeter flasks with about twenty milligrams of potassium fluorid in solution, and half a cake of compressed yeast. The yeast is broken up and evenly distributed, and the fermentation is allowed to proceed for ten days at a temperature of from 25° to 30°. At the end of this time experience has shown that all of the sucrose and invert sugar has disappeared, but the lactose remains intact. The flasks are filled to the mark with water and the lactose determined by chemical or optical methods. By comparing the data obtained from the estimation of the total reducing sugars before fermentation or inversion and the estimation of the lactose after fermentation, the quantity of invert sugar is easily calculated. The experience of this laboratory shows that invert sugar is rarely present in evaporated milks, which is an indication that the sucrose added thereto does not generally suffer hydrolysis. The mean percentage of added sucrose found in evaporated milks is about forty.
263. Occurrence.—Many bodies containing starch are presented for the consideration of the agricultural analyst. First in importance are the cereals, closely followed by the starchy root crops. Many spices and other condiments also contain starchy matters. In the sap of some plants, for instance sorghum, at certain seasons, considerable quantities of starch occur. In the analysis of cereals and other feeding stuffs, it has been the usual custom to make no separate determination of starch, but to put together all soluble carbohydrates and estimate their percentage by subtracting from 100 the sum of the percentages of the other constituents of the sample. This aggregated mass has been known as nitrogen-free extract. Recent advances in methods of investigation render it advisable to determine the starch and pentosan carbohydrates separately and to leave among the undetermined bodies the other unclassed substances, chiefly of a carbohydrate nature, soluble in boiling dilute acid and alkali. [Pg 299]
264. Separation of Starch.—Starch being insoluble in its natural state, it is impossible to separate it from the other insoluble matters of plants by any known process. In bringing it into solution it undergoes certain changes of an unknown nature, but tending to produce a dextrinoid body. Nevertheless, in order to procure the starch in a state of purity suited to analytical processes, it becomes necessary to dissolve the starch from the other insoluble bodies that naturally accompany it. As has been shown in preceding paragraphs, there are only two methods of securing the solution of starch which fully meet the conditions of accurate analysis. These are the methods depending on the use of diastatic ferments and on the employment of heat and pressure in the presence of water. These two processes have been described in considerable detail in paragraphs 179-181. It is important, in starch determinations, to remove from the sample the sugar and other substances soluble in water and also the oils, when present in large quantities, before subjecting it to the processes for rendering the starch soluble.
265. Desiccation of Amyliferous Bodies.—The removal of sugars and oils is best secured in amyliferous substances after they are deprived of their moisture. As has already been suggested, the desiccation should be commenced at a low temperature, not above 60°, and continued at that point until the chief part of the water has escaped. The operation may be conducted in one of the ways already described (pp. 12-27). There is great difference of opinion among analysts in respect of the degree of temperature to which the sample should be finally subjected, but for the purposes here in view, it will not be found necessary to go above 105°. Before beginning the operation the sample should be as finely divided as possible, and at its end the dried residue should be ground and passed through a sieve of half a millimeter mesh.
266. Indirect Method of Determining: Water in Starch.—It is claimed by Block[218] that it is necessary to dry starch at 160° in order to get complete dehydration. Wet starch as deposited with its maximum content of water has nine molecules thereof, viz., C₆H₁₀O₅ + 9H₂O. Ordinary commercial starch has about eighteen per cent of water with a formula of C₆H₁₀O₅ + 2H₂O. [Pg 300]
The percentage of water may be determined by Block’s feculometer or Block’s dose-fécule. The first apparatus determines the percentage of anhydrous starch by volume, and the second by weight.
Block’s assumption that starch can absorb only fifty per cent of its weight of water is the basis of the determination.
A noted weight of starch is rubbed up with water until saturated, the water poured off, the starch weighed, dried on blotting paper until it gives off no more moisture and again weighed. Half of the lost weight is water, from which the original per cent of water can be calculated. This at best seems to be a rough approximation and not suited to rigorous scientific determination.
267. Removal of Oil and Sugar.—The dried, finely powdered sample, obtained as described above, is placed in any convenient extractor (33-43) and the oil or fat it contains removed by the usual solvents. For ordinary purposes, even with cereals, this preliminary extraction of the oil is not necessary, but it becomes so with oily seeds containing starch. The sugar is subsequently removed by extraction with eighty per cent alcohol and the residue is then ready for the extraction of the starch. In most cases the extraction with alcohol will be found sufficient. In some bodies, for instance the sweet potato (batata), the quantity of sugar present is quite large, and generally some of it is found. If not present in appreciable amount, the alcohol extraction may also be omitted. The sample having been prepared as indicated, the starch may be brought into solution by one of the methods described in paragraphs 179-181, preference being given to the aqueous digestion in an autoclave. The dissolved starch is washed out of the insoluble residue and determined by optical or chemical methods 186-194.
268. Preparation of Diastase for Starch Solution.—The methods of preparing malt extract for use in starch analysis have been described in paragraph 179. If a purer form of diastase is desired it may be prepared by following the directions given by Long and Baker.[219] Digest 200 grams of ground malt for twenty-four hours [Pg 301] with three parts of twenty per cent alcohol. Separate the extract by filtration and to the filtrate add about one and a half liters of ninety-three per cent alcohol and stir vigorously. After the precipitate has subsided the supernatant alcohol is removed by a syphon, the precipitate is brought onto a filter and washed with alcohol of a strength gradually increasing to anhydrous, and finally with anhydrous ether. The diastase is dried in a vacuum over sulfuric acid and finally reduced to a fine powder before using. Thus prepared, it varies in appearance from a white to a slightly brownish powder. Made at different times and from separate portions of malt, it may show great differences in hydrolytic power.
269. Estimation of Starch in Potatoes by Specific Gravity.—A roughly approximate determination of the quantity of starch in potatoes can be made by determining their specific gravity. Since the specific gravity of pure starch is 1.65, it follows that the richer a potato is in starch the higher will be its specific gravity. The specific weight of substances like potatoes is conveniently determined by suspending them in water by a fine thread attached to the upper hook of a balance pan. There may be a variation of the percentage of other constituents in potatoes as well as of starch, and therefore the data obtained from the following table can only be correct on the assumption that the starch is the only variable. In practice, errors amounting to as much as two per cent may be easily made, and therefore the method is useful only for agronomic and commercial and not for scientific purposes. The method is especially useful in the selection of potatoes of high starch content for planting. The table is constructed on the weight in grams in pure water of 10000 grams of potatoes and the corresponding per cents of dry matter and starch are given. It is not always convenient to use exactly 10000 grams of potatoes for the determination, but the calculation for any given weight is easy.[220]
Example.—Let the weight of a potato in air be 159 grams, and its weight in water 14.8 grams.
Then the weight of 10000 grams of potatoes of like nature in water would be found from the equation 159: 10000 = 14.8: x.
Whence x = 931 nearly.
[Pg 302] In the table the nearest figure to 931 is 930, corresponding to 24.6 per cent of dry matter and 18.8 per cent of starch. When the number found is half way between the numbers given in the table the mean of the data above and below can be taken. In other positions a proper interpolation can be made if desired but for practical purposes the data corresponding to the nearest number can be used.
Table for Calculating Starch in Potatoes
from Specific Gravity.
| 10000 grams of potatoes weigh in water. Grams. |
Per cent dry matter. |
Per cent starch. |
|---|---|---|
| 750 | 19.9 | 14.1 |
| 760 | 20.1 | 14.3 |
| 770 | 20.3 | 14.5 |
| 780 | 20.7 | 14.9 |
| 790 | 20.9 | 15.1 |
| 800 | 21.2 | 15.4 |
| 810 | 21.4 | 15.6 |
| 820 | 21.6 | 15.8 |
| 830 | 22.0 | 16.2 |
| 840 | 22.2 | 16.4 |
| 850 | 22.4 | 16.6 |
| 860 | 22.7 | 16.9 |
| 870 | 22.9 | 17.1 |
| 880 | 23.1 | 17.3 |
| 890 | 23.5 | 17.7 |
| 900 | 23.7 | 17.9 |
| 910 | 24.0 | 18.2 |
| 920 | 24.2 | 18.4 |
| 930 | 24.6 | 18.8 |
| 940 | 24.8 | 19.0 |
| 950 | 25.0 | 19.2 |
| 960 | 25.2 | 19.4 |
| 970 | 25.5 | 19.7 |
| 980 | 25.9 | 20.1 |
| 990 | 26.1 | 20.3 |
| 1000 | 26.3 | 20.5 |
| 1010 | 26.5 | 20.7 |
| 1020 | 26.9 | 21.1 |
| 1030 | 27.2 | 21.4 |
| 1040 | 27.4 | 21.6 |
| 1050 | 27.6 | 21.8 |
| 1060 | 28.0 | 22.2 |
| 1070 | 28.3 | 22.5 |
| 1080 | 28.5 | 22.7 |
| 1090 | 28.7 | 22.9 |
| 1100 | 29.1 | 23.3 |
| 1110 | 29.3 | 23.5 |
| 1120 | 29.5 | 23.7 |
| 1130 | 29.8 | 24.0 |
| 1140 | 30.2 | 24.4 |
| 1150 | 30.4 | 24.6 |
| 1160 | 30.6 | 24.8 |
| 1170 | 31.0 | 25.0 |
| 1180 | 31.3 | 25.5 |
| 1190 | 31.5 | 25.7 |
| 1200 | 31.7 | 25.9 |
| 1210 | 32.1 | 26.3 |
| 1220 | 32.3 | 26.5 |
| 1230 | 32.5 | 26.7 |
| 1240 | 33.0 | 27.2 |
| 1250 | 33.2 | 27.4 |
| 1260 | 33.4 | 27.6 |
| 1270 | 33.6 | 27.8 |
| 1280 | 34.1 | 28.3 |
| 1290 | 34.3 | 28.5 |
| 1300 | 34.5 | 28.7 |
| 1310 | 34.9 | 29.1 |
| 1320 | 35.1 | 29.3 |
| 1330 | 35.4 | 29.6 |
| 1340 | 35.8 | 30.0 |
| 1350 | 36.0 | 30.2 |
| 1360 | 36.2 | 30.4 |
| 1370 | 36.6 | 30.8 |
[Pg 303] 270. Constitution of Cellulose.—The group of bodies known as cellulose comprises many members of essentially the same chemical constitution but of varying properties. The centesimal composition of pure cellulose is shown by the following numbers:
| Carbon, | 44.2 | per | cent |
| Hydrogen, | 6.3 | ” | ” |
| Oxygen, | 49.5 | ” | ” |
corresponding to the formula C₆H₁₀H₅.
According to the view of Cross and Bevan, cellulose conforms in respect of its ultimate constitutional groups to the general features of the simple carbohydrates, but differs from them by reason of a special molecular configuration resulting in a suppression of the activity of constituent groups in certain respects, and an increase in activity of others.[221]
271. Fiber and Cellulose.—The carbohydrates of a plant insoluble in water are not composed exclusively of starch. There are, in addition to starch, pentosan fibers yielding pentose sugars on hydrolysis and furfuraldehyd on distillation with a strong acid. The quantitive methods for estimating the pentosan bodies are given in paragraphs 150-157. The method to be preferred is that of Krug (155).
In the estimation of cattlefoods and of plant substances in general the residue insoluble in dilute boiling acid and alkali is called crude or indigestible fiber.
The principle on which the determination depends rests on the assumption that all the protein, starch and other digestible carbohydrates will be removed from the sample by successive digestion at a boiling temperature with acid and alkali solutions of a given strength. It is evident that the complex body obtained by the treatment outlined above is not in any sense a definite chemical compound, but it may be considered as being composed partly of cellulose.
272. Official Method of Determining Crude Fiber.—The method of estimating crude fiber, adopted by the Association of Official Agricultural Chemists, is as follows: [222]
[Pg 304] Extract two grams of the substance with ordinary ether, at least almost completely, or use the residue from the determination of the ether extract. To this residue, in a half liter flask, add 200 cubic centimeters of boiling 1.25 per cent sulfuric acid; connect the flask with an inverted condenser, the tube of which passes only a short distance beyond the rubber stopper into the flask. Boil at once, and continue the boiling for thirty minutes. A blast of air conducted into the flask may serve to reduce the frothing of the liquid. Filter, wash thoroughly with boiling water until the washings are no longer acid, rinse the substance back into the same flask with 200 cubic centimeters of a boiling 1.25 per cent solution of sodium hydroxid, free or nearly free of sodium carbonate, boil at once and continue the boiling for thirty minutes in the same manner as directed above for the treatment with acid. Filter into a gooch, and wash with boiling water until the washings are neutral, dry at 110°, weigh and incinerate completely. The loss of weight is crude fiber.
The filter used for the first filtration may be linen, one of the forms of glass wool or asbestos filters, or any other form that secures clear and reasonably rapid filtration. The solutions of sulfuric acid and sodium hydroxid are to be made up of the specified strength, determined accurately by titration and not merely from specific gravity.
The experience of this laboratory has shown that results practically identical with those got as above, are obtained by conducting the digestions in hard glass beakers covered with watch glasses. The ease of manipulation in the modification of the process just mentioned is a sufficient justification for its use.
273. Separation of Cellulose.—Hoppe-Seyler observed that cellulose, when melted with the alkalies at a temperature as high as 200°, was not sensibly attacked.[223]
Lange has based a process for determining cellulose on this observation.[224]
The process, as improved by him, is carried out as follows:
From five to ten grams of the substance are moistened with water and placed in a porcelain dish with about three times their weight of caustic alkali free of nitrates and about twenty cubic centimeters of water. The porcelain dish should be deep and crucible shaped and should [Pg 305] be placed in an oil-bath, the temperature of which is easily controlled. The contents of the dish are stirred with the thermometer bulb until all foaming ceases and the temperature of the mixture is then kept at from 175° to 180° for an hour. After the melt has cooled to 80° about seventy-five cubic centimeters of hot water are added to bring it into solution and it is then allowed to cool. The solution is acidified with sulfuric and placed in large centrifugal tubes. After being made slightly alkaline with soda lye, the tubes are subjected to continued energetic centrifugal action until the cellulose is separated. The supernatant liquid can be nearly all poured off and the separated cellulose is broken up, treated with hot water and again separated by centrifugal action. The cellulose is finally collected upon the asbestos felt, washed with hot water, alcohol and ether, dried and weighed. With a little practice it is possible to complete the separation of cellulose in two and one-half hours.
274. Solubility of Cellulose.—Cellulose resembles starch in its general insolubility, but, unlike starch, it may be dissolved in some reagents and afterwards precipitated practically unchanged or in a state of hydration. One of the simplest solvents of cellulose is zinc chlorid in concentrated aqueous solution.
The solution is accomplished with the aid of heat, adding one part by weight of cotton to six parts of zinc chlorid dissolved in ten parts of water.
A homogeneous sirup is obtained by this process, which is used in the arts for making the carbon filaments of incandescent electric lamps.
In preparing the thread of cellulose, the solution, obtained as described above, is allowed to flow, in a fine stream, into alcohol, whereby a cellulose hydrate is precipitated, which is freed from zinc hydroxid by digesting in hydrochloric acid.
Hydrochloric acid may be substituted for water in preparing the reagent above noted, whereby a solvent is secured which acts upon cellulose readily in the cold.
A solution of ammoniacal cupric oxid is one of the best solvents for cellulose. The solution should contain from ten to fifteen per cent of ammonia and from two to two and a half of cupric oxid. [Pg 306]
In the preparation of this reagent, ammonium chlorid is added to a solution of cupric salt and then sodium hydroxid in just sufficient quantity to precipitate all of the copper as hydroxid. The precipitate is well washed on a linen filter, squeezed as dry as possible and dissolved in ammonia of 0.92 specific gravity. The cellulose is readily precipitated from the solution in cuprammonium by the addition of alcohol, sodium chlorid, sugar, or other dehydrating agents. Solutions of cellulose are used in the arts for many purposes.[225]
275. Qualitive Reactions for Detecting Cellulose.—Cellulose may be identified by its resistance to the action of oxidizing agents, to the halogens and to alkaline solutions. It is further recognized by the sirupy or gelatinous solutions it forms with the solvents mentioned above. The cellulose hydrates precipitated from solutions have in some instances the property of forming a blue color with iodin.
A characteristic reaction of cellulose is secured as follows: To a saturated solution of zinc hydrochlorate, of 2.00 specific gravity, are added six parts by weight of potassium iodid dissolved in ten parts of water and this solution is saturated with iodin. Cellulose treated with this reagent is at once stained a deep blue violet color.[226] For the characteristics of cellulose occurring in wood the researches of Lindsey may be consulted.[227]
276. More Rarely Occurring Carbohydrates.—It is not possible here to give more space to the rarer forms of carbohydrates, to which the attention of the agricultural analyst may be called. Nearly a hundred kinds of sugars alone have been detected in the plant world. For descriptions of the properties of these bodies and the methods of their detection and determination, the standard works on carbohydrates may be consulted.[228]
[170] Vines; Physiology of Plants. Nägeli; Beiträge zur näheren Kenntniss der Stärkegruppe.
[171] Bulletin 5, Department of Agriculture, Division of Chemistry, pp. 191 et seq.: Bulletin 25, New Hampshire Experiment Station.
[172] Spencer; Handbook for Sugar Manufacturers, p. 31.
[173] Vid. op. cit. supra, pp. 102, 108.
[174] Journal of the American Chemical Society, Vol. 16, p. 677.
[175] Botanical Gazette, Vol. 12, No. 3.
[176] Bulletin de l’Association des Chimistes de Sucrerie et de Distillerie, Tome 13, p. 133.
[177] Journal of Analytical and Applied Chemistry, Vol. 4, p. 381.
[178] Spencer’s Handbook for Sugar Manufacturers, pp. 30 et seq.
[179] Bulletin de l’Association des Chimistes de Sucrerie et de Distillerie, Tome 13, p. 292.
[180] Vid. op. cit. supra, Tome 2, p. 369.
[181] Dosage du Sucre Cristallisable dans la Betterave, pp. 117 et seq.: Journal of the American Chemical Society, Vol. 16, p. 266.
[182] Neue Zeitschrift für Rübenzucker-Industrie. Band 3, S. 342; Band 14, S. 286: Zeitschrift des Vereins für die Rübenzucker-Industrie, 1876, S. 692: Dingler’s Polytechnisches Journal, Band 232, S. 461.
[183] Sidersky: Traité d’ Analyse des Matières Sucrées, p. 304.
[184] Neue Zeitschrift für Rübenzucker-Industrie, Band 14, S. 286.
[185] Zeitschrift des Vereins für die Rübenzucker-Industrie, Band 32, S. 861.
[186] Spencer’s Handbook for Sugar Manufacturers, p. 42.
[187] Bulletin No. 4 of the Chemical Society of Washington, pp. 22, et seq.
[188] Vid. op. et loc. cit. 7.
[189] Chemiker-Zeitung, Band 19, S. 1830.
[190] Vid. op cit. supra, S. 1784.
[191] Vid. op. cit. supra, S. 1829.
[192] Zeitschrift des Vereins für die Rübenzucker-Industrie, 1895, S. 844.
[193] Journal des Fabricants de Sucre, 1895, No. 33.
[194] Journal of the American Chemical Society, Vol. 2, p. 387: Agricultural Science, Feb. 1892.
[195] American Chemical Journal, Vol. 13, p. 24.
[196] Tucker; Manual of Sugar Analysis, p. 287: Wiechmann; Sugar Analysis, p. 51.
[197] Sidersky; vid. op. cit., 14, p. 197.
[198] Journal of the American Chemical Society, Vol. 18, p. 81: Allen; Commercial Organic Analysis, Vol. 1, p. 291.
[199] Handbuch der Physiologisch- und Pathologisch-Chemischen Analyse, S. 286.
[200] Kühne und Chittenden; American Chemical Journal, Vol. 6, p. 45.
[201] Vid. op. cit. supra, p. 289.
[202] Analyst, Vol. 13, p. 64.
[203] Journal American Chemical Society, Vol. 18, p. 438.
[204] School of Mines Quarterly, Vols. 11 and 12.
In a later method (School of Mines Quarterly, Vol. 13, No. 3) Wiechman describes the separation of the sugars by one polariscopic and two gravimetric determinations, one before and one after inversion. The polariscopic examination is made in a ten per cent solution at a temperature of 20°. The gyrodynats of sucrose, dextrose and levulose at the temperature mentioned are fixed at 66.5, 53.5 and -81.9 respectively. The gravimetric determinations are conducted according to the methods already described. In the formulas for calculating the results a represents sucrose, b reducing sugars, x the dextrose, y the levulose, and d the observed polarization expressed in degrees angular measure. The gyrodynats of sucrose, dextrose and levulose divided by 100 are represented by s, d and l. The calculations are made from the following formulas:
(as + xd) - yl = p.
(as + xd) = p + yl.
xd = p + yl - as.
| x = | p + yl - as |
| d |
In this calculation the gyrodynat of levulose is about ten degrees lower than that of most authorities.
[205] Vid. op. cit., 23, Band 24, S. 869.
[206] Vid. op. cit. supra, 1888, S. 782.
[207] Neue Zeitschrift für Rübenzucker-Industrie, Band 35, S. 166.
[208] Journal of the American Chemical Society, Vol. 2, p. 399: Science, Oct. 1, 1881: Proceedings American Association for the Advancement of Science, 1881, p. 61: Sugar Cane, Vol. 13, p. 533, pp. 61-66.
[209] Wiley and McElroy; Agricultural Science, Vol. 6, p. 57.
[210] Chemical News, Vol. 46, p. 175.
[211] Vid. op. cit, 14, p. 352.
[212] Vid. op. et loc. cit., 41.
[213] Vid. op. cit., 41, Vol. 65, p. 169.
[214] Zeitschrift des Vereins für die Rübenzucker-Industrie, 1884, S. 854.
[215] Bulletin 46, Division of Chemistry, U. S. Department of Agriculture, p. 60.
[216] The Analyst, Vol. 20, p. 121.
[217] Journal American Chemical Society, Vol. 15, p. 668.
[218] Comptes rendus, Tome 118, p. 147.
[219] Journal of the Chemical Society, Transactions, 1895, p. 735.
[220] Die agrikultur-chemische Versuchsstation, Halle, a/S., S. 114.
[221] Cellulose, p. 77.
[222] Vid. op. cit., 46, p. 63.
[223] Zeitschrift für physiologische Chemie, Band 13, S. 84.
[224] Zeitschrift für angewandte Chemie, 1895, S. 561.
[225] Vid. op. cit., 52, pp. 8 et seq.
[226] Vid. op. cit. supra, p. 15.
[227] Composition of Wood, Agricultural Science, Vol. 7, pp. 49, 97 and 161.
[228] Tollens; Handbuch der Kohlenhydrate: von Lippmann; Chemie der Zuckerarten.
277. Nomenclature.—The terms fat and oil are often used interchangeably and it is difficult in all cases to limit definitely their application. The consistence of the substance at usual room temperatures may be regarded as a point of demarcation. The term fat, in this sense, is applied to glycerids which are solid or semi solid, and oil to those which are quite or approximately liquid. A further classification is found in the origin of the glycerids, and this gives rise to the groups known as animal or vegetable fats and oils. In this manual, in harmony with the practices mentioned above, the term fat will be used to designate an animal or vegetable glycerid which is solid, and the term oil one which is liquid at common room temperature, viz., about 20°. There are few animal oils, and few vegetable fats when judged by this standard, and it therefore happens that the term oil is almost synonymous with vegetable glycerid and fat with a glycerid of animal origin. Nearly related to the fats and oils is the group of bodies known as resins and waxes. This group of bodies, however, can be distinguished from the fats and oils by chemical characteristics. The waxes are ethers formed by the union of fatty acids and alcohols of the ethane, and perhaps also of the ethylene series.[229] This chemical difference is not easily expressed and the terms themselves often add confusion to the meaning, as for instance, japan wax is composed mostly of fats, and sperm oil is essentially a wax.
278. Composition.—Fats and oils are composed chiefly of salts produced by the combination of the complex base glycerol with the fat acids. Certain glycerids, as the lecithins, contain also phosphorus in organic combinations, nitrogen, and possibly other inorganic constituents in organic forms. By the action of alkalies the glycerids are easily decomposed, the acid combining with the inorganic base and [Pg 310] the glycerol becoming free. The salts thus produced form the soaps of commerce and the freed base, when collected and purified, is the glycerol of the trade.
When waxes are decomposed by alkalies, fatty acids and alcohols of the ethane series are produced.
The natural glycerids formed from glycerol, which is a trihydric (triatomic) alcohol, are found in the neutral state composed of three molecules of the acid, united with one of the base. If R represent the radicle of the fat acid the general formula for the chemical process by which the salt is produced is:
| Glycerol. | Acid. | Salt. | Water. | ||
| O.H | O.R | ||||
| C₃H₅ | O.H | + 3R.OH = | C₃H₅ | O.R | + 3H₂O. |
| O.H | O.R | ||||
The resulting salts are called triglycerids or neutral glycyl ethers.[230] In natural animal and vegetable products, only the neutral salts are found, the mono- and diglycerids resulting from artificial synthesis. For this reason the prefix tri is not necessarily used in designating the natural glycerids, stearin, for instance, meaning the same as tristearin.
279. Principal Glycerids.—The most important glycerids which the analyst will find are the following:
| Olein, | C₃H₅O(O.C₁₈H₃₃O)₃. |
| Stearin, | C₃H₅O(O.C₁₈H₃₅)₃. |
| Palmitin, | C₃H₅O(O.C₁₆H₃₁O)₃. |
| Linolein, | C₃H₅O(O.C₁₈H₃₁O)₃. |
| Butyrin, | C₃H₅O(O.C₄H₇O)₃. |
Olein is the chief constituent of most oils; palmitin is found in palm oil and many other natural glycerids; stearin is a leading constituent of the fats of beeves and sheep, and butyrin is a characteristic constituent of butter, which owes its flavor largely to this glycerid and its nearly related concomitants.
280. Extraction of Oils and Fats.—Preparatory to a physical and chemical study of the fats and oils is their separation from the other organic matters with which they may be associated. In the case of animal tissues this is usually accomplished by the application of heat. [Pg 311] The operation known as rendering may be conducted in many different ways. For laboratory purposes, the animal tissues holding the fat are placed in a convenient dish and a degree of heat applied which will liquify all the fat particles and free them from their investing membranes. The temperature employed should be as low as possible to secure the desired effect, but fats can be subjected for some time to a heat of a little more than 100°, without danger of decomposition. The direct heat of a lamp, however, should not be applied, since it is difficult to avoid too high a temperature at the point of contact of the flame and dish. The dry heat of an air-bath or rendering in an autoclave or by steam is preferable. The residual animal matter is subjected to pressure and the combined liquid fat freed from foreign matters by filtering through a jacket filter, which is kept at a temperature above the solidifying point of the contents.
On a large scale, as in rendering lard, the fat is separated by steam in closed vats which are strong enough to withstand the steam pressure employed. For analytical purposes it is best to extract the fat from animal tissues in the manner described, since the action of solvents is slow on fat particles enveloped in their containing membranes, and the fats, when extracted, are liable to be contaminated with extraneous matters. In dried and ground flesh meal, however, the fat may be extracted with the usual solvents. For the quantitive determination of fat in bones or flesh, the sample, as finely divided as possible, is thoroughly dried, and the fat separated from an aliquot finely powdered portion by extraction with chloroform, ether, or petroleum. The action of anhydrous ether on dried and powdered animal matters is apparently a continuous one. Dormeyer has shown that even after an extraction of several months additional matter goes into solution.[231] The fat in such cases can be determined by saponification with alcoholic potash and the estimation of the free fatty acids produced.
From vegetable substances, such as seeds, the fat is extracted either by pressure or by the use of solvents. For quantitive purposes, only solvents are employed. The dry, finely ground material is exhausted with anhydrous ether or petroleum spirit, in one of the convenient [Pg 312] forms of apparatus already described (33->43). In very oily seeds great difficulty is experienced in securing a fine state of subdivision suited to complete extraction. In such cases it is advisable to conduct the process in two stages. In the first stage the material, in coarse powder, is exhausted as far as possible and the percentage of oil determined. The residue is then easily reduced to a fine powder, in an aliquot part of which the remaining oil is determined in the usual way.

Fig. 79.—Oil Press.
In securing oils for physical and chemical examination both pressure and solution may be employed. The purest oils are secured by pressure at a low temperature. To obtain anything like a good extraction some sort of hydraulic pressure must be used. In this laboratory a press is employed in which the first pressure is secured by a screw and this is [Pg 313] supplemented by hydraulic pressure in which glycerol is the transmitting liquid. The construction of the press is shown in the accompanying figure.
The whole press is warmed to nearly 100°. The hot finely ground oily material, enclosed in a cloth bag, is placed in the perforated cylinder and compressed as firmly as possible by turning with the hands the wheel shown at the top of the figure. The final pressure is secured by the screw shown at the bottom of the figure whereby a piston is driven into a cylinder containing glycerol. The degree of pressure obtained is equal to 300 atmospheres.
Even with the best laboratory hydraulic pressure not more than two-thirds of the total oil contents of oleaginous seeds can be secured and the process is totally inapplicable to securing the oil from tissues when it exists in quantities of less than ten per cent. To get practically all of the oil the best method is to extract with carefully distilled petroleum of low boiling point.
In the preparation of this reagent the petroleum ether of commerce, containing bodies boiling at temperatures of from 35° to 80°, is repeatedly fractioned by distillation until a product is obtained which boils at from 45° to 60°. The distillation of this material is conducted in a large flask heated with steam, furnished with a column containing a number of separatory funnels and connected with an appropriate condenser. The distillate is secured in a bottle packed with broken ice, as shown in Fig. 80. A thermometer suspended in the vapor of the petroleum serves to regulate the process. Too much care to avoid accidents cannot be exercised in this operation. Not only must steam be used in heating, but all flame and fire must be rigidly excluded from the room in which the distillation takes place, and the doors leading to other rooms where gas jets may be burning must be kept closed. In the beginning of the process, as much as possible of the petroleum boiling under 45° must be removed and rejected. The distillation is then continued until the temperature rises above 60°. The parts of the distillate saved between these temperatures are redistilled under similar conditions. Other portions of the petroleum, boiling at other temperatures, may be secured in the same way. The [Pg 314] products may be in a measure freed of unpleasant odors by redistilling them from a mixture with lard. When used for quantitive purposes the petroleum ether must leave no residue when evaporated at 100°.

Fig. 80.—Apparatus for Fractional Distillation
of Petroleum Ether.
281. Freeing Extracted Oils from Petroleum.—The petroleum ether which is used for extracting oils tends to give them an unpleasant odor and flavor and its entire separation is a matter of some difficulty. The greater part of the solvent may be recovered as described in paragraph 43. Heating the extracted oil for several hours in thin layers, will remove the last traces of the solvent, but affords [Pg 315] opportunity for oxidation, especially in the case of drying oils. An effective means of driving off the last traces of petroleum is to cause a current of dry carbon dioxid to pass through the sample contained in a cylinder and heated to a temperature of from 85° to 90°. The atmosphere of the inert gas will preserve the oil from oxidation and the sample will, as a rule, be found free of the petroleum odor after about ten hours treatment. Ethyl ether or chloroform may be used instead of petroleum, but these solvents act on other matters than the glycerids, and the extract is therefore liable to be contaminated with more impurities than when the petroleum ether is employed. Other solvents for fats are carbon tetrachlorid, carbon disulfid, and benzene. In general, petroleum ether should be employed in preference to other solvents, except in the case of castor oil, which is difficultly soluble in both petroleum and petroleum ethers.
282. Freeing Fats Of Moisture.—Any excess of water in glycerids will accumulate at the bottom of the liquid sample and can be removed by decanting the fat or separating it from the oil by any other convenient method. The warm oil may be almost entirely freed of any residual moisture by passing it through a dry filter paper in a jacket funnel kept at a high temperature. A section showing the construction of such a funnel with a folded filter paper in place, is shown in Fig. 81. The final drying, when great exactness is required, is accomplished in a vacuum, or in an atmosphere of inert gas, or in the cold in an exsiccator over sulfuric acid. In drying, it is well to expose the hot oil as little as possible to the action of the air. Wherever convenient, it should be protected from oxidation by some inert gas or a vacuum.
283. Sampling for Analysis.—It is a matter of some difficulty to secure a representative sample of a fat or oil for analytical purposes. The moisture in a fat is apt to be unevenly distributed, and the sampling is to be accomplished in a manner to secure the greatest possible uniformity. When the quantity of material is of considerable quantity a trier may be used which will remove a cylindrical or partly cylindrical mass from the whole length or depth. By securing several [Pg 316] subsamples of this kind, and well mixing them, an average sample of the whole mass may be secured. Where the fat is found in different casks or packages samples should be drawn from each as described above. The subsamples are mixed together in weights corresponding to the different casks from which they are taken and the mass obtained by this mixture divided into three equal portions. Two of these parts are melted in a dish at a temperature not exceeding 60°, with constant stirring, and when fully liquid the third part is added. As a rule, the liquid fat retains enough heat to melt the added quantity. As soon as the mixed fats begin to grow pasty the mass is vigorously stirred to secure an intimate mixture of the water and other foreign bodies.[232]

Fig. 81.—Section Showing Construction of a Funnel
for Hot Filtration.
In the case of butter fat the official chemists recommend that subsamples be drawn from all parts of the package until about 500 grams are secured. The portions thus drawn are to be perfectly melted in a [Pg 317] closed vessel at as low a temperature as possible, and when melted the whole is to be shaken violently for some minutes till the mass is homogeneous, and sufficiently solidified to prevent the separation of the water and fat. A portion is then poured into the vessel from which it is to be weighed for analysis, and this should nearly or quite fill it. This sample should be kept in a cold place till analyzed.[233]
284. Estimation of Water.—In the official method for butter fat, which may be applied to all kinds, about two grams are dried to constant weight, at the temperature of boiling water, in a dish with flat bottom, having a surface of at least twenty square centimeters.
The use of clean dry sand or asbestos is admissible, and is necessary if a dish with round bottom be employed.
In the method recommended by Benedikt, about five grams of the sampled fat are placed in a small flask or beaker and dried at 100° with occasional stirring to bring the water to the surface.
According to the method of Sonnenschein, the sample is placed in a flask carrying a cork, with an arrangement of glass tubes, whereby a current of dry air may be aspirated over the fat during the process of drying. When the flask is properly fitted its weight is taken, the fat put in and reweighed to get the exact amount. The fat is better preserved by aspirating carbon dioxid instead of air.[234] The moisture may also be readily determined by drying on pumice stone, as described in paragraph 26. In this case it is well to conduct the desiccation in vacuum or in an inert atmosphere to prevent oxidation.
285. Specific Gravity.—The specific gravity of an oil is readily determined by a westphal balance (53), by a spindle, by a sprengel tube, or more accurately by a pyknometer. The general principles governing the conduct of the work have already been given (48-59). The methods described for determining the density of sugar solutions are essentially the same as those used for oils, but it is to be remembered that oils and fats are lighter than water and the [Pg 318] graduation of the sinkers for the hydrostatic balance, and the spindles for direct determination must be for such lighter liquids. The necessity of determining the density of a fat at a temperature above its melting point is manifest, and for this reason the use of the pyknometer at a high temperature (40° to 100°) is to be preferred to all the other processes, in the case of fats which are solid at temperatures below 25°.

Fig. 82.—Balance and Westphal Sinker.
When great delicacy of manipulation is desired, combined with rapid work, an analytical balance and westphal sinker may be used conjointly.[235] In this case it is well to have two or three sinkers graduated for 20°, 25°, and 40°, respectively. Nearly all fats, when melted and cooled to 40°, remain in a liquid state long enough to determine their density. The sinkers are provided with delicate thermometers, and the temperature, which at the beginning is a little above the degree at which the sinker is graduated, is allowed to fall to just that degree, when the equilibrium is secured in the usual manner. The sinker is [Pg 319] conveniently made to displace just five grams of distilled water at the temperature of graduation, but it is evident that a round number is not necessary, but only convenient for calculation.
286. Expression of Specific Gravity.—Much confusion arises in the study of data of densities because the temperatures at which the determinations are made are not expressed. The absolute specific gravity would be a comparison of the weight of the object at 4°, with water at the same temperature. It is evident that such determinations are not always convenient, and for this reason the determinations of density are usually made at other temperatures.
In the case of a sinker, which at 35° displaces exactly five grams of water, the following statements may be made: One cubic centimeter of water at 35° weighs 0.994098 gram. The volume of a sinker displacing five grams of water at that temperature is therefore 5.0297 cubic centimeters. This volume of water at 4° weighs 5.0297 grams. In a given case the sinker placed in an oil at 35° is found to displace a weight equal to 4.5725 grams corresponding to a specific gravity of 35°/35° = 0.9145. From the foregoing data the following tabular summary is constructed:
| Weight | of | 5.0287 | cubic | centimeters | of | oil | at 35°, | 4.5725 | grams. |
| ” | ” | 5.0297 | ” | ” | ” | water | at 35°, | 5.0000 | ” |
| ” | ” | 5.0297 | ” | ” | ” | ” | ” 4°, | 5.0297 | ” |
| Relative | weight | of | oil | at | 35°, | to | water | at | 35°, | 0.9145 | grams. |
| ” | ” | ” | ” | ” | 35°, | ” | ” | ” | 4°, | 0.9092 | ” |
287. Coefficient of Expansion of Oils.—Oils and fats of every kind have almost the same coefficient of expansion with increasing temperature. The coefficient of expansion is usually calculated by the formula
| δ = | D₀ - D₀ʹ |
| (tʹ - t)D₀ |
in which δ represents the coefficient of expansion, D₀ the density at the lowest temperature, D₀ʹ the density at the highest temperature, t the lowest, and tʹ the highest temperatures.
In the investigations made by Crampton it was shown that the formula would be more accurate, written as follows:[236]
| δ = |
D₀ - D₀ʹ |
| (tʹ - t) × D₀ + D₀ʹ | |
| 2 |
[Pg 320] The absolute densities can be calculated from the formula Δ = δ + K, in which Δ represents the coefficient of absolute expansion, δ the apparent coefficient of expansions observed in glass vessels, and K the cubical coefficient of expansion of the glass vessel. The mean absolute coefficient of expansion for fats and oils, for 1° as determined by experiment, is almost exactly 0.0008, and the apparent coefficient of expansion nearly 0.00077.[237]
288. Standard of Comparison.—In expressing specific gravities it is advisable to refer them always to water at 4°. The temperature at which the observation is made should also be given. Thus the expression of the specific gravity of lard, determined at different temperatures, is made as follows:
| 15°.5 | |
| d —— = | 0.89679; |
| 4° | |
| 40° | |
| d —— = | 0.91181; |
| 4° | |
| 100° | |
| and d —— = | 0.85997, |
| 4° | |
indicating the relative weights of the sample under examination at 15°.5, 40°, and 100°, respectively, to water at 4°.
289. Densities of Common Fats and Oils.—It is convenient to have at hand some of the data representing the densities of common fats and oils, and the following numbers are from results of determinations made in this laboratory:[238]
| 15°.5 | 40° | 100° | ||||
|---|---|---|---|---|---|---|
| Temperature. | d = | —. | d = | —. | d = | —. |
| 4° | 4° | 4° | ||||
| Leaf lard | 0.91181 | 0.89679 | 0.85997 | |||
| Lard stearin | 0.90965 | 0.89443 | 0.85750 | |||
| Oleostearin | 0.90714 | 0.89223 | 0.85572 | |||
| Crude cottonseed oil | 0.92016 | 0.90486 | 0.86739 | |||
| Summer ” ” | 0.92055 | 0.90496 | 0.86681 | |||
| Winter ” ” | 0.92179 | 0.90612 | 0.86774 | |||
| Refined ” ” | 0.92150 | 0.90573 | 0.86714 | |||
| Compound lard ” | 0.91515 | 0.90000 | 0.86289 | |||
| Olive oil | 0.91505 | 0.89965 | 0.86168 | |||
290. Melting Point.—The temperature at which fats become sensibly liquid is a physical characteristic of some importance. Unfortunately, the line of demarcation between the solid and liquid states of this class of bodies is not very clear. Few of them pass per saltum from one state to the other. In most cases there is a gradual transition, which, between its initial and final points, may show a difference of several degrees in temperature. It has been noted, [Pg 321] further, that fats recently melted behave differently from those which have been solid for several hours. For this reason it is advisable, in preparing glycerids for the determination of their melting point, to fuse them the day before the examination is to be made. The temperature at which a glycerid passes from a liquid to a solid state is usually higher than that at which it resumes its solid form. If, however, the change of temperature could be made with extreme slowness, exposing the sample for many hours at near its critical temperature, these differences would be much less marked.
Many methods have been devised for determining the melting point of fats, and none has been found that is satisfactory in every respect. In some cases the moment at which fluidity occurs is assumed to be that one when the small sample loses its opalescence and becomes clear. In other cases the moment of fluidity is determined by the change of shape of the sample or by observing the common phenomena presented by a liquid body. In still other cases, the point at which the sample becomes fluid is determined by the automatic completion of an electric circuit, which is indicated by the ringing of a bell. This latter process has been found very misleading in our experience. Only a few of the proposed methods seem to demand attention here, and some of those, depending on the visible liquefaction of a small quantity of the fat or based on the physical property, possessed by all liquids when removed from external stress, of assuming a spheroidal state will be described. Other methods which may demand attention in any particular case may be found in the works cited.[239]
291. Determination in a Capillary Tube.—A capillary tube is dipped into the melted fat and when filled one end of the tube is sealed in the lamp and it is then put aside in a cool place for twenty-four hours. At the end of this time the tube is tied to the bulb of a delicate thermometer the length used or filled with fat being of the same length as the thermometer bulb. The thermometer and attached fat are placed in water, oil, or other transparent media, and gently warmed until the capillary column of fat becomes transparent. At this moment the thermometric reading is made and entered as the melting [Pg 322] point of the fat. In comparative determinations the same length of time should be observed in heating, otherwise discordant results will be obtained. As in all other methods, the resulting members are comparative and not absolute points of fusion, and the data secured by two observers on the same sample may not agree, if different methods of preparing the fat and different rates of fusion have been employed.

Fig. 83.—
Melting
Point
Tubes.
Several modifications of the method just described are practiced, and perhaps with advantage in some cases. In one of these a small particle of the fat is solidified in a bulb blown on a small tube, as indicated in Fig. 83, tube a. The tube, in an upright position, is heated in a convenient bath until the particle of fat just begins to run assuming soon the position shown in tube b. This temperature is determined by a thermometer, whose bulb is kept in contact with the part of the observation tube containing the fat particle. The rise of temperature is continued until the fat collected at the bottom of the bulb is entirely transparent. This is called the point of complete fusion.[240]
Pohl covers the bulb of a thermometer with a thin film of fat, and the instrument is then fixed in a test tube, in such a way as not to touch the bottom, and the film of fat warmed by the air-bath until it fuses and collects in a droplet at the end of the thermometer bulb.[241]
Carr has modified this process by inserting the thermometer in a round flask in such a way that the bulb of the thermometer is as nearly as possible in the center. By this device the heating through the intervening air is more regular and more readily controlled.[242]
A particle of fat placed on the surface of clean mercury will melt when the mercury is raised to the proper temperature. Where larger quantities of the fat are employed, a small shot or pellet of mercury may be placed upon the surface and the whole warmed until the metal [Pg 323] sinks. Of the above noted methods, the analyst will find some form of capillary tube or the use of a film of the fat on the bulb of a thermometer the most satisfactory.[243]
Hehner and Angell have modified the sinking point method by increasing the size of the sinker without a corresponding increase in weight. This is accomplished by blowing a small pear-shaped float, nearly one centimeter in diameter and about two long. The stem of the pear is drawn out and broken off, and while the bulb is still warm, the open end of the stem is held in mercury, and a small quantity of this substance, sufficient in amount to cause the float to sink slowly through a melted fat, is introduced into the bulb of the apparatus and the stem sealed. The whole bulb should displace about one cubic centimeter of liquid and weigh, after filling with mercury, about three and four-tenths grams. In conducting the experiment about thirty grams of the dry melted fat are placed in a large test tube and cooled by immersing the tube in water at a temperature of 15°. The tube containing the solidified fat is placed in a bath of cold water and the sinker is placed in the center of the surface of the fat. The bath is slowly heated until the float disappears. The temperature of the bath is read just as the bulb part of the float disappears. The method is recommended especially by the authors for butter fat investigations.[244]
298. Melting Point Determined by the Spheroidal State.—The method described by the author, depending on the assumption of the spheroidal state of a particle of liquid removed from all external stress, has been found quite satisfactory in this laboratory, and has been adopted by the official chemists.[245] In the preparation of the apparatus there are required:
(a) a piece of ice floating in distilled water that has been recently boiled, and (b) a mixture of alcohol and water of the same specific gravity as the fat to be examined. This is prepared by boiling distilled water and ninety-five per cent alcohol for a few minutes to remove the gases which they may hold in solution. While still hot, the water is poured into the test tube described below until it is nearly half full. The test tube is then nearly filled with the hot alcohol, which is carefully poured down the side of the inclined tube to avoid too much mixing. If the alcohol is not added until the [Pg 324] water has cooled, the mixture will contain so many air bubbles as to be unfit for use. These bubbles will gather on the disk of fat as the temperature rises and finally force it to the top.

Fig. 84.—Apparatus for the
Determination of Melting point.
The apparatus for determining the melting point is shown in Fig. 84, and consists of (a) an accurate thermometer reading easily tenths of a degree; (b) a cathetometer for reading the thermometer (but this may be done with an eye-glass if held steadily and properly adjusted); (c) a thermometer; (d) a tall beaker, thirty-five centimeters high and ten in diameter; (e) a test tube thirty centimeters long and three and a half in diameter; (f) a stand for supporting the apparatus; (g) some method of stirring the water in the beaker (for example, a blowing bulb of rubber, and a bent glass tube extending to near the bottom of the beaker).
The disks of fat are prepared as follows: The melted and filtered fat is allowed to fall from a dropping tube from a height of about twenty cubic centimeters on a smooth piece of ice floating in recently boiled distilled water. The disks thus formed are from one to one and a half centimeters in diameter and weigh about 200 milligrams. By pressing the ice under the water the disks are made to float on the surface, whence [Pg 325] they are easily removed with a steel spatula, which should be cooled in the ice water before using. They should be prepared a day or at least a few hours before using.
The test tube containing the alcohol and water is placed in a tall beaker, containing water and ice, until cold. The disk of fat is then dropped into the tube from the spatula, and at once sinks until it reaches a part of the tube where the density of the alcohol-water is exactly equivalent to its own. Here it remains at rest and free from the action of any force save that inherent in its own molecules.
The delicate thermometer is placed in the test tube and lowered until the bulb is just above the disk. In order to secure an even temperature in all parts of the alcohol mixture in the vicinity of the disk, the thermometer is gently moved from time to time in a circularly pendulous manner.
The disk having been placed in position, the water in the beaker is slowly heated, and kept constantly stirred by means of the blowing apparatus already described.
When the temperature of the alcohol-water mixture rises to about 6° below the melting point, the disk of fat begins to shrivel, and gradually rolls up into an irregular mass.
The thermometer is now lowered until the fat particle is even with the center of the bulb. The bulb of the thermometer should be small, so as to indicate only the temperature of the mixture near the fat. A gentle rotatory movement from time to time should be given to the thermometer bulb. The rise of temperature should be so regulated that the last 2° of increment require about ten minutes. The mass of fat gradually approaches the form of a sphere, and when it is sensibly so the reading of the thermometer is to be made. As soon as the temperature is taken the test tube is removed from the bath and placed again in the cooler. A second tube, containing alcohol and water, is at once placed in the bath. The test tube (ice water having been used as a cooler) is of low enough temperature to cool the bath sufficiently. After the first determination, which should be only a trial, the temperature of the bath should be so regulated as to reach a maximum of about 1°.5 above the melting point of the fat under examination. [Pg 326]
The edge of the disk should not be allowed to touch the sides of the tube. This accident rarely happens, but in case it should take place, and the disk adhere to the sides of the tube, a new trial should be made.
Triplicate determinations should be made, and the second and third results should show a near agreement.
Example.—Melting point of sample of butter:
| Degrees. | |
| First trial | 33.15 |
| Second trial | 33.05 |
| Third trial | 33.00 |
The fatty acids, being soluble in alcohol, cannot be treated as the ordinary glycerids. But even those glycerids which are slightly soluble in alcohol may be subjected to the above treatment without fear of experiencing any grave disturbance of the fusing points.
293. Solidifying Point.—The temperature at which a fat shows incipient solidification is usually lower than the point of fusion. The same difficulties are encountered in determining the temperature of solidification as are presented in observing the true melting point. The passage from a transparent liquid to an opaque solid is gradual, showing all the phases of turbidity from beginning opalescence to complete opacity. The best the analyst can do is to determine, as accurately as possible, the temperature at which the more solid glycerids of the mixture begin to form definite crystals. This point is affected to a marked degree by the element of time. A fat cooled just below its melting point will become solid after hours, or days, whereas it could be quickly cooled far below that temperature and still be limpid.
The methods of observation are the same for the glycerids and fatty acids, and the general process of determination is sufficiently set forth in the following description of the method as used in this laboratory.[246]

Fig. 85.—Apparatus
for Determining
Crystallizing Point.
The melted fat or fat acid is placed in a test tube contained in a large bottle, which serves as a jacket to protect the tube from sudden or violent changes of temperature. The efficiency of the jacket may be [Pg 327] increased by exhausting the air therefrom, as in the apparatus for determining the heat of bromination, hereafter described. A very delicate thermometer, graduated in tenths of a degree, and having a long bulb, is employed. By means of the reading glass, the reading can be made in twentieths of a degree. The arrangement of the apparatus is shown in Fig. 85. The test tube is nearly filled with the melted matter. The bottom of the jacket should be gently warmed to prevent a too rapid congelation in the bottom of the test tube containing the melted fat, and the tube is to be so placed as to leave an air space between it and the bottom of the bottle. The thermometer is suspended in such a manner as to have the bulb as nearly as possible in the center of the melted fat. The thermometer should be protected from air currents and should be kept perfectly still. In case the congealing point is lower than room temperature the jacket may be immersed in a cooling mixture, the temperature of which is only slightly below the freezing point of the fatty mass.
When crystals of fat begin to form, the descent of the mercury in the stem of the thermometer will become very slow and finally reach a minimum, which should be noted. As the crystallization extends inwards and approaches the bulb of the thermometer a point will be reached when the mercury begins to rise. At this time the partially crystallized mass should be vigorously stirred with the thermometer and again left [Pg 328] at rest in as nearly, the original position as possible. By this operation the mercury will be made to rise and its maximum position should be noted as the true crystallizing point of the whole mass. In comparing different samples, it is important that the elements of time in which the first crystallization takes place should be kept, as nearly as possible, the same. A unit of one hour in cooling the mixture from a temperature just above its point of fusion until the incipient crystallization is noticed, is a convenient one for glycerids and for fat acids.
294. Determination of Refractive Power.—The property of refracting light is possessed by fats in different degrees and these differences are of great help in analytical work. The examination may be made by the simple refractometer of Abbe or Bertrand, or by the more elaborate apparatus of Pulfrich.
The comparative refractive power of fats can also be observed by means of the oleorefractometer of Amagat-Jean or the differential refractometer of Zune.[247]
For details of the construction of these apparatus, with a description of the optical principles on which they are based, the papers above cited may be consulted. In this laboratory the instruments which have been employed are three in number, viz., Abbe’s small refractometer, Pulfrich’s refractometer using yellow light, and the oleorefractometer of Amagat-Jean. A brief description of the methods of manipulating these instruments is all that can be attempted in this manual.
295. Refractive Index.—Refractive index is an expression employed to characterize the measurement of the degree of deflection caused in a ray of light in passing from one transparent medium into another. It is the quotient of the sine of the angle of the incident, divided by the sine of the angle of the refracted ray.
In the case of oils which remain liquid at room temperatures, the determinations can be made without the aid of any device to maintain liquidity. In the case of fat which becomes solid at ordinary room temperatures, the determination must either be made in a room artificially warmed or the apparatus must have some device, as in the [Pg 329] later instruments of Abbe and Pulfrich, and in the apparatus of Amagat-Jean, whereby the sample under examination can be maintained in a transparent condition. In each case the accuracy of the apparatus should be tested by pure water, the refractive index of which at 18° is 1.333. The refractive index is either read directly on the scale as in Abbe’s instrument, or calculated from the angles measured as in Pulfrich’s apparatus.

Fig. 86.—Abbe’s Refractometer.
296. Abbe’s Refractometer.—For practical use the small instrument invented by Abbe will be found sufficient. The one which has been in use for many years in this laboratory is shown in Fig. 86. The illustration represents the apparatus in the position preliminary to reading the index. In preparing the sample of oil for observation the instrument is turned on its axis until the prisms between which the oil is placed assume a horizontal position, as is seen in Fig. 87. The movable prism is unfastened and laid aside, the fixed prism covered with a rectangular shaped piece of tissue paper on which one or two drops of the oil are placed. The movable prism is replaced in such a manner as to secure a complete separation of the two prisms by the film of oiled tissue paper. A little practice will enable the analyst to secure this result.
After the paper disk holding the fat is secured by replacing the upper prism, the apparatus is placed in its normal position and the index moved until the light directed through the apparatus by the mirror shows the field of vision divided into dark and light portions. The dispersion apparatus is now turned until the rainbow colors on the part between the dark and light fields have disappeared. Before doing this, however, the telescope, the eyepiece of the apparatus, is so adjusted [Pg 330] as to bring the cross lines of the field of vision distinctly into focus. The index of the apparatus is now moved back and forth until the line of the two fields of vision falls exactly at the intersection of the cross lines. The refractive index of the fat under examination is then read directly upon the scale by means of a small magnifying glass. To check the accuracy of the first reading, the dispersion apparatus should be turned through an angle of 180° until the colors have again disappeared, and, after adjustment, the scale of the instrument again read. These two readings should nearly coincide, and their mean is the true reading of the fat under examination.

Fig. 87.—Charging Position of Refractometer.
For butter fats the apparatus should be kept in a warm place, the temperature of which does not fall below 30°. For reducing the results obtained to a standard temperature, say 25°, the factor 0.000176 may be used. As the temperature rises the refractive index falls.
Example.—Refractive index of a butter fat determined at 32°.4 = 1.4540, reduced to 25° as follows: 32.4 -25 = 7.4; 0.000176 × 7.4 = 0.0013; then 1.4540 + 0.0013 = 1.4553.
[Pg 331] The instrument used should be set with distilled water at 18°, the theoretical refractive index of water at that temperature being 1.333. In the determination above given, the refractive index of pure water measured 1.3300; hence the above numbers should be corrected for theory by the addition of 0.0030, making the corrected index of the butter fat mentioned at the temperature given, 1.4583.
297. Pulfrich’s Refractometer.—For exact scientific measurements, Pulfrich’s apparatus has given here entire satisfaction. In this instrument a larger quantity of the oil is required than for the abbe, and this quantity is held in a cylindrical glass vessel luted to the top of the prism. The method of accomplishing this and also an illustration of the refraction of the rays of light are shown in Fig. 88.

Fig. 88.—Prism of Pulfrich’s
Refractometer.
The angle i is measured by a divided circle read with the aid of a small telescope. The index of the prism of highly refractive glass N is known. The oil is seen at n. The light used is the yellow sodium ray (D). From the observed angle the refractive index of n is calculated from the formula
| n = | √ | N² - sin²i. |
For convenience the values of n for all usual values of i are computed once for all and arranged for use in tabular form. The latest model of Pulfrich’s apparatus, arranged both for liquid and solid bodies, and also for spectrometric observation is shown in Fig. 89.
When the sodium light is used it is placed behind the apparatus and the light is collected and reflected on the refractive prism by the lens N. Through H and G is secured the micrometric reading of the angle on the scale D by means of the telescopic arrangement F E. For regulating the temperature of the oil and adjacent parts, a stream of water at any desired temperature is made to circulate through L and S in the direction indicated by the arrows. The manner in which this is accomplished is shown in the cross section of that part of the apparatus as indicated in Fig. 90. [Pg 332]

Fig. 89.—Pulfrich’s New Refractometer.

Fig. 90.—
Heating Apparatus
for Pulfrich’s
Refractometer.

Fig. 91.—Spectrometer Attachment.
For further details of the construction and operation of the apparatus the original description may be consulted.[248]
In case a spectrometric observation is desired the H ray, for instance, is produced by the geissler tube Q, Fig. 91. The light is concentrated and thrown upon the refractive prism by the lens P, the lens N, Fig. 89, being removed for this purpose.
Tables, for correcting the dispersion and for calculating the indices for each angle and fraction thereof, and for corrections peculiar to the apparatus, accompany each instrument.
298. Refractive Indices of some Common Oils.—The following [Pg 334] numbers show the refractive indices obtained by Long for some of the more common oils. The light used was the yellow ray of the sodium flame.[249]
| Name. | Temperature. | Refractive index. |
Calculated for 25°. |
|
|---|---|---|---|---|
| Olive oil (France) | 26°.6 | 1.4673 | 1.4677 | |
| ” ” (California) | 25°.4 | 1.4677 | 1.4678 | |
| Cottonseed | oil | 24°.8 | 1.4722 | 1.4721 |
| ” | ” | 26°.3 | 1.4703 | 1.4709 |
| ” | ” | 25°.3 | 1.4718 | 1.4719 |
| Sesamé | oil | 24°.8 | 1.4728 | 1.4728 |
| ” | ” | 26°.8 | 1.4710 | 1.4716 |
| Castor | ” | 25°.4 | 1.4771 | 1.4773 |
| Lard | ” | 27°.3 | 1.4657 | 1.4666 |
| Peanut | ” | 25°.3 | 1.4696 | 1.4696 |
In case of the use of Abbe’s apparatus, in which diffused sunlight is the source of the illumination, the numbers obtained cannot be compared directly with those just given unless the apparatus be first so adjusted as to read with distilled water at 18°, 1.333. In this case the reading of the scale gives the index as determined by the yellow ray. The numbers obtained with Abbe’s instrument for some common oils are given below.[250]
In the determinations the instrument was set with water at 18°, reading 1.3300, and they were corrected by adding 0.0030 in order to compensate for the error of the apparatus.
| Material. | Calculated for 25°. |
Corrected index. |
|---|---|---|
| Lard | 1.4620 | 1.4650 |
| Cotton oil | 1.4674 | 1.4704 |
| Olive oil stearin | 1.4582 | 1.4610 |
| Lard stearin | 1.4594 | 1.4624 |
299. Oleorefractometer.—Instead of measuring the angular value of the refractive power of an oil it may be compared with some standard on a purely arbitrary scale. Such an apparatus is illustrated by the oleorefractometer of Amagat-Jean, or by Zeiss’s butyrorefractometer.
In the first named instrument, Fig. 92, the oil to be examined is compared directly with another typical oil and the shadow produced by the difference in refraction is located on a scale read by a telescope and graduated for two different temperatures.[251] The internal structure of the apparatus is shown in Fig. 93. [Pg 335]

Fig. 92.—Oleorefractometer.

Fig. 93.—Section Showing Construction of Oleorefractometer.
[Pg 336] In the center of the apparatus a metal cylinder, A, is found carrying two plate glass pieces, C B, so placed as to form an angle of 107°. This cylinder is placed in a larger one, provided with two circular glass windows. To these two openings are fixed to the right and left, the telescopic attachments, G, V, S, E, and the apparatus M, H, Sʹ, Eʹ, for rendering the rays of light parallel. The field of vision is divided into two portions, light and dark, by a semicircular stop inserted in the collimator, and contains the double scale shown in the figure placed at H. The field of vision is illuminated by a gas or oil lamp placed at a convenient distance from the collimator. The inner metallic cylinder A is surrounded with an outer one, to which the optical parts are attached at D Dʹ by means of plane glass plates. This cylinder is in turn contained in the large water cylinder P P, carrying a thermometer in the opening shown at the top on the left. The manipulation of the apparatus is very simple. The outer cylinder is filled with water, at a temperature below 22°, the middle one with the typical oil furnished with the instrument, the cover of the apparatus carrying the thermometer placed in position and the cup-shaped funnel inserted in the cylinder A, which is at first also filled with the typical oil. The whole system is next brought slowly to the temperature of 22° by means of the lamp shown in Fig. 92. The telescope is adjusted to bring the scale of the field of vision into focus and the line dividing the light and shadow of the field should fall exactly on 0°a. If this be not the case the 0° is adjusted by screws provided for that purpose until it is in proper position. The typical oil is withdrawn from A by the cock R, the cylinder washed with a little of the oil to be examined and then filled therewith. On again observing the field of vision the line separating the shadow from the light will be found moved to the right or left, if the oil have an index different from that of the typical oil. The position of the dividing line is read on the scale.
For fats the temperature of the apparatus is brought exactly to 45° and the scale 0°b is used. In other respects the manipulation for the fats is exactly that described for oils. In the use of 0°a, in case the room [Pg 337] be warmer than 22°, all the liquids employed should be cooled below 22° before being placed in the apparatus. It is then only necessary to wait until the room temperature warms the system to 22°. In the case of fats it is advisable to heat all the liquids to about 50° and allow them to cool to 45° instead of heating them to that temperature by means of the lamp.
One grave objection to this instrument is found in the absence of the proper scientific spirit controlling its manufacture and sale, as evidenced by the attempt to preserve the secret of the composition of the typical oil and the negligence in testing the scale of the instruments which will be pointed out further along.
According to Jean[252] the common oils, when purified, give the following readings at 22°:
| Peanut | oil | +3.5 | to | +6.5 |
| Colza | ” | +17.5 | ” | +21.0 |
| Cotton | ” | +18.0 | ” | +18.0 |
| Linseed | ” | +47.0 | ” | +54.5 |
| Lard | ” | +5.5 | ” | +5.5 |
| Olive | ” | +1.5 | ” | 0.0 |
| Sesamé | ” | +17.5 | ” | +19.0 |
| Oleomargarin | -15.0 | ” | -15.0 | |
| Butter | fat | -30.0 | ” | -30.0 |
| Mutton | oil | 0.0 | ” | 0.0 |
| Fish | ” | +38.0 | ” | +38.0 |
In this instrument, therefore, vegetable and fish oils, as a rule, show a right hand, and animal fats a left hand deviation.
The oleorefractometer has been extensively used in this laboratory and the data obtained thereby have been found useful. We have not found, however, the values fixed by Jean to be constant. The numbers for lard have varied from -3.0 to -10.0, and other fats have shown almost as wide a variation from the values assigned by him.
Jean states that the number for lard, determined by the oleorefractometer, is -12, and he gives a definite number for each of the common oils and fats. On trying the pure lards of known origin in this instrument, I have never yet found one that showed a deviation of -12 divisions of the scale; but I have no doubt that there are many such lards in existence. The pure normal lards derived from the fat of [Pg 338] a single animal would naturally show greater variations in their chemical and physical properties, than a typical lard derived from the mixed fats of a great many animals. In leaf lard, rendered in the laboratory, the reading of the oleorefractometer was found to be -10°, while with the intestinal lard it was -9°. On the other hand, a lard rendered from the fat from the back of the animal showed a reading of only -3°, and a typical cottonseed oil a reading of +12°. According to the statement of Jean, a lard which gives even as low a refractive number as -9, by his instrument, would be adjudged at least one-quarter cottonseed oil.
After a thorough trial of the instrument of Jean, I am convinced that it is of great diagnostic value, but if used in the arbitrary manner indicated by the author it would lead to endless error and confusion. In other words, this instrument is of greater value in analyses than Abbe’s ordinary refractometer, because it gives a wider expansion in the limits of the field of vision, and therefore can be more accurately read, but it is far from affording a certain means of discovering traces of adulteration with other fats.
300. Variations in the Instruments.—In the use of the oleorefractometer, attention should be called to the fact that, through some negligence in manufacture, the instruments do not give, in all instances, the same reading with the same substance. Allen obtained the following data with a sample of lard examined in three instruments, viz., 4°.5, 6°, and 11°. Such wide differences in the scales of the instruments cannot fail to disparage the value of comparative determinations.
The variations in samples of known origin, when read on the same instrument, however, will show the range of error to which the determinations made with the oleorefractometer are subject. Pearmain has tabulated a large number of observations of this kind, covering 240 samples of oils.[253]
Following are the data relating to the most important oils. [Pg 339]
| At 22°. | |||
|---|---|---|---|
| Name of oil. | Highest reading. Degrees. |
Lowest reading. Degrees. |
Mean reading. Degrees. |
| Almond | 10.5 | 8.0 | 9.5 |
| Peanut | 7.0 | 5.0 | 6.0 |
| Castor | 42.0 | 39.0 | 40.0 |
| Codliver | 46.0 | 40.0 | 44.0 |
| Cottonseed (crude) | 17.0 | 16.0 | 16.5 |
| ”(refined) | 23.0 | 17.0 | 21.5 |
| Lard oil | -1.0 | 0.0 | 0.0 |
| Linseed (crude) | 52.0 | 48.0 | 50.0 |
| ” (refined) | 54.0 | 50.0 | 52.5 |
| Olive | 3.5 | 1.0 | 2.0 |
| Rape | 20.0 | 16.0 | 17.5 |
| Sesamé | 17.0 | 13.0 | 15.5 |
| Sunflower | 35.0 | 35.0 | 35.0 |
| Tallow oil | -5.0 | -1.0 | -3.0 |
| Oleic acid | -33.0 | -29.0 | -32.0 |
| At 45°. | |||
| Butter | -34.0 | -25.0 | -30.0 |
| Oleomargarin | -18.0 | -13.0 | -15.0 |
| Lard | -14.0 | -8.0 | -10.5 |
| Tallow | -18.0 | -15.0 | -16.0 |
| Paraffin | 58.5 | 54.0 | 56.0 |

Fig. 94.—Butyrorefractometer.
301. Butyrorefractometer.—Another instrument graduated on an arbitrary scale is the butyrorefractometer of Zeiss. This apparatus, which resembles in some respects the instrument of Abbe, differs therefrom essentially in dispensing with the revolving prisms of Amici, whereby the chromatic fringing due to dispersion is corrected, and on having the scale fixed for one substance, in this instance, pure butter fat. The form of the instrument is shown in Fig. 94. The achromatization for the butter fat is secured in the prisms between which a film of the fat is placed, as in the Abbe instrument. When a fat, differing from that for which the instrument is graduated is introduced, the fringes of the dark and light portions of the field will not only be colored (difference in dispersion), but the line of [Pg 340] separation will also be displaced (difference in refractive power). The apparatus is therefore used in the differential determination of these two properties. It must not be forgotten, however, that butter fats differ so much in these properties among themselves as to make possible the condemnation of a pure as an adulterated sample.
302. Method of Charging the Apparatus.—The prism casing of the instrument is opened by turning the pin F to the right and pushing the half B of the prism casing aside. The prism and its appendages must be cleaned with the greatest care, the best means for this purpose being soft clean linen moistened with a little alcohol or ether.
Melt the sample of butter in a spoon and pour it upon a small paper filter held between the fingers and apply the first two or three drops of clear butter fat so obtained to the surface of the prism contained in prism casing B. For this purpose the apparatus should be raised with the left hand so as to place the prism surface in a horizontal position.
Press B against A and replace F by turning it in the opposite direction into its original position; thereby B is prevented from falling back and both prism surfaces are kept in close contact.
303. Method of Observation.—While looking into the telescope, give the mirror J such a position as to render the critical line which separates the bright left part of the field from the dark right part distinctly visible. It may also be necessary to move or turn the instrument about a little. First it will be necessary to ascertain whether the space between the prism surfaces be uniformly filled with butter, for, if not, the critical line will not be distinct.
By allowing a current of water of constant temperature to flow through the apparatus, some time previous to the taking of the reading, the at first somewhat hazy critical line approaches in a short time, generally after a minute, a fixed position and quickly attains its greatest distinctness. When this point has been reached note the appearance of the critical line (i. e., whether colorless or colored and in the latter case of what color); also note the position of the critical line on the centesimal scale, which admits of the tenth divisions being [Pg 341] conveniently estimated, and at the same time read the thermometer. By making an extended series of successive readings and by employing an assistant for melting and preparing the small samples of butter, from twenty-five to thirty refractometric butter tests may, after a little practice, be made in an hour.
The readings of the refractive indices of a large number of butter samples made at 25° are, by means of a table which will be found below, directly reduced to scale divisions and yield the following equivalents:[254]
| Natural butter | (1.4590-1.4620) : 49.5-54.0 | scale | divisions. |
| Margarin | (1.4650-1.4700) : 58.6-66.4 | ” | ” |
| Mixtures | (1.4620-1.4690) : 54.0-64.8 | ” | ” |
Whenever, in the refractometric examination of butter at a temperature of 25°, higher values than 54.0 are found for the critical lines these samples will, according to Wollny, by chemical analysis, always be found to be adulterated; but in all samples in which the value for the position of the critical line does not fall below 52.5, chemical analysis maybe dispensed with and the samples may be pronounced to be pure butter.
In calculating the position of the critical line for other temperatures than 25° allow for 1° variation of temperature a mean value of 0.55 scale division. The following table, which has been compiled in this manner, shows the values corresponding to various temperatures, each value being the upper limit of scale divisions admissible in pure butter:
| Temp. | Sc. div. | Temp. | Sc. div. | Temp. | Sc. div. | Temp. | Sc. div. |
| 45° | 41.5 | 40° | 44.2 | 35° | 47.0 | 30° | 49.8 |
| 44° | 42.0 | 39° | 44.8 | 34° | 47.5 | 29° | 50.3 |
| 43° | 42.6 | 38° | 45.3 | 33° | 48.1 | 28° | 50.8 |
| 42° | 43.1 | 37° | 45.9 | 32° | 48.6 | 27° | 51.4 |
| 41° | 43.7 | 36° | 46.4 | 31° | 49.2 | 26° | 51.9 |
| 40° | 44.2 | 35° | 47.0 | 30° | 49.8 | 25° | 52.5 |
If, therefore, at any temperature between 45° and 25° values be found for the critical line, which are less than the values corresponding to the same temperature according to the table, the sample of butter may safely be pronounced to be natural, i. e., unadulterated butter. If the reading show higher numbers for the critical line the sample should be reserved for chemical analysis. A special thermometer for use in the examination of butter will be described in the section devoted to dairy products. [Pg 342]
304. Range of Application of the Butyrorefractometer.—The extended range of the ocular scale of the refractometer, n = 1.42 to 1.49, which embraces the refractive indices of the majority of oils and fats, renders the instrument applicable for testing oils and fats and also for examining glycerol.
By reference to the subjoined table the scale divisions may be transformed into terms of refractive indices. It gives the refractive indices for yellow light for every ten divisions of the scale. The differential column Δ gives the change of the refractive indices in terms of the fourth decimal per scale division. Owing to the accuracy with which the readings can be taken (0.1 scale division) the error of the value of n rarely exceeds one unit of the fourth decimal of n.
Table of Refractive Indices.
| Scale div. | nD. | Δ. | Scale div. | nD. | Δ. |
|---|---|---|---|---|---|
| 0 | 1.4220 | 8.0 | 50 | 1.4593 | 6.6 |
| 10 | 1.4300 | 7.7 | 60 | 1.4650 | 6.4 |
| 20 | 1.4377 | 7.5 | 70 | 1.4723 | 6.0 |
| 30 | 1.4452 | 7.2 | 80 | 1.4783 | 5.7 |
| 40 | 1.4524 | 6.9 | 90 | 1.4840 | 5.5 |
| 50 | 1.4593 | 100 | 1.4895 |
The process of observation is precisely the same as that already described. In cases, however, where the critical line presents very broad fringes (turpentine, linseed oil, etc.) it is advisable to repeat the reading with the aid of a sodium flame.
305. Viscosity.—An important property of an oil, especially when its lubricating qualities are considered, is the measure of the friction which the particles exert on other bodies and among themselves, in other words, its viscosity. In the measure of this property no definite element can be considered, but the analyst must be content with comparing the given sample with the properties of some other liquid regarded as a standard. The usual method of procedure consists in determining the time required for equal volumes of the two liquids to pass through an orifice of given dimensions, under identical conditions of temperature and pressure. In many instances the viscosity of oils is determined by comparing them with water or rape oil, while, [Pg 343] in other cases, a solution of sugar is employed as the standard of measurement.
In case rape oil be taken as a standard and its viscosity represented by 100 the number representing the viscosity of any other oil may be found by multiplying the number of seconds required for the outflow of fifty cubic centimeters by 100 and dividing by 535. If the specific gravity vary from that of rape oil, viz., 0.915, at 15°, a correction must be made by multiplying the result obtained above by the specific gravity of the sample and dividing the product by 0.915. If n be the observed time of outflow in seconds and s the specific gravity the viscosity is expressed as follows:[255]
| V = | n × 100 × s | = | n × 100 × s |
| 535 × 0.195 | 489.525 |

Fig. 95.—
Doolittle’s
Viscosimeter.
It is important that the height of the oil in the cylinders from which it is delivered be kept constant, and this is secured by supplying additional quantities, on the principle of the mariotte bottle.
306. The Torsion Viscosimeter.—In this laboratory the torsion viscosimeter, based on the principle described by Babcock is used. The instrument employed is the one described by Doolittle.[256] The construction of the apparatus is illustrated in Fig. 95.
A steel wire is suspended from a firm support and fastened to a stem which passes through a graduated horizontal disk, thus permitting the accurate measurement of the torsion of the wire. The disk is adjusted so that the index point reads exactly 0, thus showing that there is no torsion in the wire. A brass cylinder seven centimeters long by five in diameter, having a slender stem by which to suspend it, is [Pg 344] immersed in the oil and fastened by a thumbscrew to the lower part of the stem of the disk. The oil cup is surrounded by a bath of water or high fire-test oil, according to the temperature at which it is desired to determine the viscosity. This temperature obtained, while the disk is resting on its supports, the wire is twisted 360° by rotating the milled head at the top. The disk being released, the cylinder rotates in the oil by virtue of the torsion of the wire.
The action now observed is identical with that of the simple pendulum.
If there were no resistance to be overcome, the disk would return to 0, and the momentum thus acquired would carry it 360° in the opposite direction. But the resistance of the oil to the rotation of the cylinder causes the revolution to fall short of 360°, and the greater the viscosity of the oil the greater will be the resistance, and also the retardation. This retardation is found to be a very delicate measure of the viscosity of the oil.
This retardation may be read in a number of ways, but the simplest is to read directly the number of degrees of retardation between the first and second complete arcs covered by the rotating pendulum. For example, suppose the wire be twisted 360° and the disk released so that rotation begins. In order to obtain an absolute reading to start from, which shall be independent of any slight error in adjustment, ignore the starting point and make the first reading of the index at the end of the first swing. The disk is allowed to complete a vibration and the needle is read again at its nearest approach to the first point read. The difference in the two readings will measure the retardation due to the viscosity of the liquid. In order to eliminate errors duplicate determinations are made, the milled head being rotated in an opposite direction in the second one. The mean of the two readings will represent the true retardation. Each instrument is standardized in a solution of pure cane sugar, as proposed by Babcock, and the viscosity, in each case, is a number representing the number of grams of sugar in 100 cubic centimeters, which, at 22°, would produce the retardation noted.
Each instrument is accompanied by a table which contains the necessary [Pg 345] corrections for it and the number expressing the viscosity, corresponding to the different degrees of retardation, as read on the index. The following numbers, representing the viscosity of some oils as determined by the method of Doolittle, were obtained by Krug.[257]
| Peanut | oil | 48.50 |
| Olive | ” | 53.00 |
| Cottonseed | ” | 46.25 |
| Linseed | ” | 33.50 |
307. Microscopic Appearance.—When fats are allowed to slowly crystallize from an ethereal solution they may afford crystalline forms, which, when examined with a magnifying glass, yield valuable indications of the nature and origin of the substance under examination.[258]
The method of securing fat crystals for microscopic examination, which has been used in this laboratory, is as follows: From two to five grams of the fat are placed in a test tube and dissolved in from ten to twenty cubic centimeters of ether. The tube is loosely stoppered with cotton and allowed to stand, for fifteen hours or longer, in a moderately warm room where no sudden changes of temperature are likely to take place. It is advisable to prepare several solutions of the same substance with varying properties of solvent, for it is not possible to secure in a given instance those conditions which produce the most characteristic crystals. The rate and time of the crystallization should be such that the microscopic examination can take place when only a small portion of the fat has separated in a crystalline condition. A drop of the mass containing the crystals is removed by means of a pipette, placed on a slide, a drop of cotton or olive oil added, a cover glass gently pressed down on the mixture and the preparation subjected to microscopic examination. Several slides should be prepared from the same or different crystallizations. Sometimes the results of an examination made in this way are very definite, but the analyst must be warned not to expect definite data in all cases. Often the microscopic investigations result in the production of negative or misleading observations, and, at best, this method of procedure must be regarded only as helpful and confirmatory.
A modification of the method of preparation described above has been [Pg 346] suggested by Gladding.[259] About five grams of the melted fat are placed in a small erlenmeyer, dissolved in a mixture of ten cubic centimeters of absolute alcohol mixed with half that quantity of ether. The flask is stoppered with a plug of cotton and allowed to stand in a cool place for about half an hour. By this treatment the more easily crystallizable portions of the fat separate in a crystalline form, while the triolein and its nearly related glycerids remain in solution. The crystalline product is separated by filtration through paper wet with alcohol and washed once with the solvent mentioned above. After drying in the air for some time the crystals are removed from the paper and dissolved in twenty-five cubic centimeters of ether, the cotton plug inserted, and the erlenmeyer placed, in a standing position, in a large beaker containing water. The water jacket prevents any sudden changes of temperature and affords an opportunity for the uniform evaporation of the ether which should continue for fifteen hours or longer in a cool place.
Other solvents, viz., alcohol, chloroform, carbon disulfid, carbon tetrachlorid, petroleum and petroleum ether have been extensively used in the preparation of fat crystals for microscopic examination, but in our experience none of these is equal to ether when used as already described.
308. Microscopic Appearance of Crystals of Fats.—For an extended study and illustration of the characteristics of fat crystals the bulletin of the Division of Chemistry, already cited, may be consulted. In the case of lard, there is a tendency, more or less pronounced, to form prismatic crystals with rhombic ends. Beef fat on the other hand shows a tendency to form fan-shaped crystals in which the radii are often curved.
Typical crystals of swine and beef fat are shown in the accompanying figures, 96 and 97.[260] In mixtures of swine and beef fats the typical crystals are not always developed, but in most cases the fan-shaped crystals of the beef fat will appear more or less modified when that fat forms twenty per cent or more of the mixture. When only five or ten per cent of the beef fat on the one hand or a like amount of swine fat on the other are present the expectation of developing any characteristic crystals of the minimum constituent is not likely to be realized. [Pg 347]
The typical crystals of lard are thought by some experts to be palmitin and those of beef fat stearin, but no direct evidence has been adduced in support of these a priori theories.
In the experience of this laboratory, as described by Crampton,[261] the differences between the typical crystallization of beef and swine fats are plainly shown. In mixed fats, on the contrary, confusing observations are often made. In a mixture of ten per cent of beef and ninety per cent of swine fats a uniform kind of crystallization is observed, not distinctly typical, but the characteristics of the lard crystals predominate. In many cases a positive identification of the crystals is only made possible by repeated crystallizations. In the examination of so-called refined lards, which are mixtures of lard and beef fat, the form of aggregation of the crystals is found to resemble the fan-shaped typical forms of beef fat. When the single crystals, however, are examined with a higher magnifying power, they are not found to be pointed but blunt, and some present the appearance of plates with oblique terminations, but not so characteristic as those obtained from pure lard. In other cases in compound lards no beef fat crystals are observed and these lards may have been made partly of cotton oil stearin. When a lard crystal presents its edge to observation it may readily escape identification, or may even be mistaken for a crystal of beef fat. In order to insure a side view the cover glass should be pressed down with a slight rotatory movement, whereby some of the lard crystals at least may be made to present a side view.
309. Observation of Fat Crystals with Polarized Light.—The appearance of fat crystals, when observed by means of polarized light alone or with the adjunct of a selenite plate, is often of value in distinguishing the nature and origin of the sample.[262]
Every fat and oil which is amorphous will present the same set of phenomena when observed with polarized light through a selenite plate, but when a fat has been melted and allowed to cool slowly the field of vision will appear mottled and particolored when thus examined. This method has been largely used in the technical examination of butter for [Pg 348] adulterants, and the microscope is extensively employed by the chemists of the Bureau of Internal Revenue for this purpose. In the examination of the crystals of butter fat by polarized light a cross is usually observed when the nicols are turned at the proper angle, but the cross, while almost uniformly seen with butter, is not distinctive, since other fats often show it. These forms of crystals are best obtained by heating the butter fat to the boiling-point of water for about a minute and then allowing it to slowly solidify, and stand for twenty-four hours.
Pure butter, properly made, is never subjected to fusion, and hence, when examined through a selenite plate, presents a uniform field of vision similarly illuminated and tinted throughout. In oleomargarin, the fats are sometimes, during their preparation, in a fused condition. The field of vision is therefore filled to a greater or less extent with crystals more or less perfect in form. Some of these crystals, being doubly refracting, will impart to a selenite field a mottled appearance. Such a phenomenon is therefore indicative of a fraudulent butter or of one which has been at some time subjected to a temperature at or above its fusing point.
310. Spectroscopic Examination of Oils.—The presence of chlorophyll or of its alteration products is a characteristic of crude oils of vegetable origin. In refined oils, even when of a vegetable origin, all traces of the chlorophyll products may disappear. The absorption bands given by oils are not all alike and in doubtful cases a suspected sample should be compared with one of known origin.
In conducting the examination, the oil in a glass vessel with parallel sides, is placed in front of the slit of the spectroscope and any absorption band is located by means of the common divided scale and by the color of the spectrum on which it falls. Olive and linseed oils give three sharply defined absorption bands, a very dark one in the red, a faint one on the orange and a well marked one in the green.
Sesame, arachis, poppyseed and cottonseed oils also show absorption bands. Castor and almond oils do not affect the spectrum.
Fig. 96.

Lard Crystals × 65.
Fig. 97.

Refined Lard (beef fat) Crystals × 65.
A. Hoen & Co., Lithocaustic.
[Pg 349] Rape and flaxseed oils absorb a part of the spectrum but do not affect the rest of it. The spectroscope is of little practical utility in oil analysis.[263]
311. Critical Temperature of Solution.—The study of the critical temperature of solution of oils has been made by Crismer, who finds it of value in analytical work.[264] If a fatty substance be heated under pressure, with a solvent, e. g., alcohol, it will be noticed that as the temperature rises the meniscus of separation of the two liquids tends to become a horizontal plane. If at this point the contents of the tube be thoroughly mixed by shaking and then be left at rest, a point will soon be reached at which the two liquids again separate, and this point is distinctly a function of temperature. Following is a description of a convenient method of determining the critical temperature of the solution of fats and oils for experimental purposes. Tubes are prepared for holding the reagents in such a way that, after the introduction of the fat and alcohol, they can be easily sealed. The capacity of these tubes should be about five cubic centimeters. They should be charged with about one cubic centimeter of the dry filtered fat and about twice that quantity of ninety-five per cent alcohol. Care should be exercised to avoid touching the upper sides of the tube with the reagents. When charged the tubes are sealed in the flame of a lamp and attached to the bulb of a delicate thermometer in such a manner as to have the surface of its liquid contents even with the top of the bulb. The tube is conveniently fastened to the thermometer by a platinum wire. For duplicate determinations two tubes may be fastened to the same thermometric bulb. The apparatus thus prepared is placed in a large vessel filled with strong sulfuric acid. The operator should be careful to protect himself from the danger which might arise from an explosion of the sealed tubes during heating. It is advisable in all cases to observe the reaction through a large pane of clear glass. The bath of sulfuric acid is heated by any convenient means and an even temperature throughout the mass is secured by stirring with the thermometer and its attachments. When the meniscus which separates the two liquids becomes a horizontal plane the thermometer is removed and the liquid in the tubes well mixed [Pg 350] until it appear homogeneous. The thermometer is replaced in the bath, which is allowed to cool slowly, and the phenomena which take place in the sealed tubes are carefully noted. The critical temperature of solution is that at which the two liquids begin to separate. This moment is easily noted. It is, moreover, preceded by a similar phenomenon taking place in the capillary part of the tube which retains a drop of the mixture on shaking. In this droplet an opalescence is first noted. In the mass of the liquid this opalescence, a few seconds afterwards, is observed to permeate the whole, followed by the formation of zones and finally of the reappearance of the meniscus of separation between the two liquids. The temperature at this moment of opalescence preceding the separation of the liquid is the critical temperature of solution. With alcohol of 0.8195 specific gravity, at 15°.5 (ninety-five per cent), the observed critical temperatures for some of the more common fats and oils are as given below:
| Butter fat | 100°.0 | |
| Oleomargarin | 125°.0 | |
| Peanut | oil | 123°.0 |
| Cotton | ” | 116°.0 |
| Olive | ” | 123°.0 |
| Sesamé | ” | 121°.0 |
| Colza | ” | 132°.5 |
| Mutton tallow | 116°.0 | |
| Beef marrow | 125°.0 | |
| Nut oil | 100°.5 | |
When the alcohol is not pure or if it be of a different density from that named, the numbers expressing the critical temperature of solution will vary from those given above.
312. Polarization.—The pure glycerids are generally neutral to polarized light. In oils the degree of polarization obtained is often variable, sometimes to the right and sometimes to the left. Olive oil, as a rule, shows a slight right hand polarization. Peanut, sesamé, and cottonseed oils vary in polarizing power, but in no case is it very marked. Castor oil polarizes slightly to the right.
In determining the polarizing power of an oil it should be obtained in a perfectly limpid state by filtration and observed through a tube of [Pg 351] convenient length, as a rule, 200 millimeters. The deviation obtained may be expressed in divisions of the sugar scale of the instrument or in degrees of angular rotation.
313. Turbidity Temperature.—The turbidity temperature of a fat, when dissolved in glacial acetic acid, as suggested by Valenta, may prove of some diagnostic value.[265] The fats are dissolved, with the aid of heat, in glacial acetic acid and, on slowly cooling, the temperature at which they become turbid is observed. The following data observed by Jones are given for comparison.[266]
The numbers represent the turbidity temperature of the fat when treated with the glacial acetic acid, and allowed to cool slowly. Butter fat, from 40° to 70°, mostly from 52° to 65°; oleomargarin, 95° to 106°; rape oil, 101°; sesamé oil, 77°; linseed oil, 53° to 57°; lard oil, 96°; olive oil, 89°; peanut oil, 61° to 88°.
It is important in this test that the acetic acid be absolutely glacial. About three cubic centimeters of the glacial acetic acid, and three of the fat, should be used.
314. Solubility in Alcohol.—As has already been noted, the glycerids are freely soluble in ether, chloroform, carbon bisulfid, acetone, carbon tetrachlorid, and some other less commonly used solvents. Their solubility in absolute alcohol is variable and the determination of its degree may often be useful in analytical work.
The method used by Milliau for determining the degree of solubility is as follows:[267] The fatty matter is deprived of its free acids by shaking for half an hour with twice its volume of ninety-five per cent alcohol. After standing until the liquids are separated, the oil or fat is drawn off and washed three times with distilled water. The sample is deprived of water by filtering through a hot jacket filter and a given weight of the dry sample is well shaken with twice its weight of absolute alcohol. A weighed portion of the alcoholic solution obtained is evaporated to remove the alcohol and the weight of the residual fat determined. From the data obtained the percentage of solubility is [Pg 352] calculated. Olive oils, when treated as described above, show a solubility of about forty-three parts per thousand of absolute alcohol, cotton oil sixty-two parts, sesamé forty-one parts, peanut sixty-six parts, colza twenty parts, and flaxseed seventy parts per thousand.
315. Coloration Produced by Oxidants.—When oils and fats are mixed with oxidizing reagents, such as sulfuric and nitric acids, the glycerids are partly decomposed with the production of colors which have some analytical significance. The most simple method of applying these tests is by the use of a thick porcelain plate provided with small cup-shaped depressions for holding the few drops of material required. Two or three drops of the oil under examination are placed in each of the cups, a like quantity of the oxidizing reagent added, and the mixture stirred with a small glass rod. The colors produced are carefully noted and the mixture is allowed to remain at room temperature for at least twelve hours in order that the final tint may be observed. The sulfuric acid used for this reaction should have a specific gravity of one and seven-tenths and the nitric acid should have the usual commercial strength of the strongest acid. Pure lard, when treated with sulfuric acid, as above described, shows but little change of color while the vegetable oils mostly turn brown or black. In addition to the reagents mentioned many others, including sulfuric and nitric acids, sulfuric acid and potassium bichromate, chlorin, ammonia, hydrogen peroxid, sodium hydroxid and aqua regia are used. Only a few of these tests seem to have sufficient analytical importance to merit any detailed description.[268]
316. Coloration in Large Masses.—Instead of applying the color test in the small way just described, larger quantities of the fat may be used, either in the natural state or after solution in petroleum or other solvent. For this purpose about ten cubic centimeters of the oil are shaken with a few drops of sulfuric acid or sulfuric and nitric acids. Lard, when thus treated (five drops of sulfuric acid to ten cubic centimeters of lard) shows practically no coloration. When treated with an equal volume of sulfuric acid and shaken, the lard on separating has a brown-red tint.[269]
[Pg 353] Olive oil, with a few drops of sulfuric acid, gives a green color, while cottonseed, peanut and other vegetable oils, when thus treated with sulfuric and nitric acids, show brown to black coloration. The delicacy of the reaction may be increased by first dissolving the fat or oil in petroleum ether.
In the use of the coloration test with solvents, a convenient method is to dissolve about one cubic centimeter of the fat in a test tube in petroleum ether, add one drop of strong sulfuric acid and shake.
In the case of lard, the color does not change or becomes yellow or red. Cottonseed oil, similarly treated, shows a brown or black color.[270]
317. Special Nitric Acid Test.—A special nitric acid test for cottonseed oil is made with nitric acid of exactly 1.375 specific gravity at 15°. This test is especially valuable in detecting cottonseed in olive oil. The operation is conveniently conducted by shaking together equal volumes of the oil and acid in a test tube until an intimate mixture or emulsion is secured. When any considerable quantity of cottonseed oil is present an immediate brown coloration is produced, from the intensity of which the relative proportion of cottonseed oil in the case of a mixture may be roughly approximated. When only a little cottonseed oil is present in the mixture, the test tube containing the reagents should be set aside for several hours before the final observation is made.
318. Coloration with Phosphomolybdic Acid.—Among the color tests, one which we have found of use is the coloration produced in certain oils, mostly of a vegetable origin, by phosphomolybdic acid.[271]
The method of applying the test is extremely simple. A few cubic centimeters of the oil or melted lard are dissolved in an equal volume of chloroform, and a third volume of ten per cent phosphomolybdic acid added. The mouth of the test tube is closed with the thumb, and the whole is violently shaken. On being left in repose, the phosphomolybdic acid gathers at the top, and the coloration produced therein is easily observed. Cottonseed oil and peanut oil both give a beautiful green when [Pg 354] treated in this way, which is turned to a blue on the addition of ammonia. Linseed oil gives a green color, but forms a kind of emulsion which obscures the color to some extent. The pure lards rendered in the laboratory give no coloration whatever to the reagent, but it retains its beautiful amber color in every case. Mixtures containing as little as ten per cent cottonseed oil and ninety per cent lard, show a distinct greenish tint, while twenty per cent cottonseed oil gives a distinct green. This reaction, therefore, may be considered of great value, and on account of its easy application it should come into wide use. But it is probable that different samples of cottonseed oil, refined to different degrees or in different ways, vary in their deportment with phosphomolybdic acid as they do with silver nitrate. In other words, there may be some samples of cottonseed oil which will not give the green color when treated as above, or so faintly as to have no diagnostic value in mixtures.
This reaction shows itself with nearly all vegetable oils but those which have been chemically treated either for the purpose of bleaching, or for the removal of the acidity, do not respond to the test at all, or else in a feeble manner, and that only after standing some time. Lard, goose fat, tallow, deer fat, butter fat, etc., show no change in color on being treated with this reagent, either with or without the addition of alkali. The presence of a small quantity of vegetable oil betrays itself by the appearance of the above mentioned coloration, the intensity of which forms an approximate measure of the amount of vegetable oil present in the sample. In experiments with suspected lards, which deviated in their iodin absorption numbers from those of genuine lard, the results were concordant, the color deepening as the iodin figure rose. The mineral fats (paraffin, vaselin) are without action on this reagent, and the only animal fat which reduces it is codliver oil.
In like manner some samples of lard may be found which exhibit a deportment with this reagent similar to that shown with vegetable oils, and tallow and lard oil have been shown to give more distinct reactions than some of the vegetable oils.[272]
The phosphomolybdic acid may be prepared by precipitating a solution of [Pg 355] ammonium molybdate with sodium phosphate and dissolving the washed precipitate in a warm solution of sodium carbonate. The solution is evaporated to dryness and the dry residue subjected to heat. If a blue coloration be produced it may be discharged by adding a little nitric acid and reheating. The residue is dissolved in water, acidified with nitric and made of such a strength as to contain about ten per cent of the substance.
319. Coloration with Picric Acid.—If to ten cubic centimeters of oil a cold saturated solution of picric acid in ether be added and the latter be allowed to evaporate slowly, the acid remains dissolved in the oil, to which it communicates a brown color.
Pure lard, after the evaporation of the ether, appears of a citron-yellow color; if cottonseed oil be present, however, the mixture assumes a brown-red color.[273]
320. Coloration with Silver Nitrate.—A modification of Bechi’s method of reducing silver nitrate, given further on, has been proposed by Brullé.[274] The reagent employed consists of twenty-five parts of silver nitrate in 1,000 parts of alcohol of ninety-five per cent strength. Twelve cubic centimeters of the oil to be examined and five of the reagent are placed in a test tube, held in a vessel containing boiling water, and the ebullition continued for about twenty minutes. At the end of this time an olive oil, even if it be an impure one, will show a beautiful green tint. With seed oils the results are quite different. Cotton oil submitted to this treatment becomes completely black. Peanut oil shows at first a brown-red coloration and finally a somewhat green tint, losing its transparency. Sesamé oil is distinguished by a red-brown tint very pronounced and remaining red. Colza oil takes on a yellowish green coloration, becomes turbid and is easily distinguished in its reaction from olive oil. In mixtures of olive oil with the other oils, any notable proportion of the seed oils can be easily determined by the above reactions. Natural butter treated with this reagent retains its primitive color. That containing margarin becomes a brick-red and as little as five per cent of margarin in butter can be detected by this test. With ten per cent the tint is very pronounced. [Pg 356]
321. Coloration with Stannic Bromid.—This reagent is prepared by adding dry bromin, drop by drop, to powdered or granulated tin held in a flask immersed in ice water, until a persistent red color indicates that the bromin is in excess. In the application of this reagent three or four drops of it are added successively to a little less than that quantity of the oil, the mixture well stirred and set aside for a few minutes. The unsaponifiable matters of castor oil give a green color when thus treated, sandal wood oil a blood-red color and cedar oil a purplish color.[275]
322. Coloration with Auric Chlorid.—The use of auric chlorid for producing colorations in oils and fats was first proposed by Hirschsohn.[276] One gram of auric chlorid is dissolved in 200 cubic centimeters of chloroform and about six drops of this reagent added to five cubic centimeters of the oil to be tested. In the case of cottonseed oil a beautiful red color is produced.
I have found that even pure lards give a trace of color sometimes with this reagent, and therefore the production of a slight red tint cannot in all cases be regarded as conclusive of the presence of cottonseed oil.[277]
In general, it may be said that the color reactions with fats and oils have a certain qualitive and sorting value, and in any doubtful case they should not be omitted. Their value can only be established by comparison under identical conditions with a large number of fats and oils of known purity. The analyst must not depend too confidingly on the data found in books, but must patiently work out these reactions for himself.
323. Thermal Reactions.—The measurement of the heat produced by mixing glycerids with reagents which decompose them or excite other speedy chemical reactions, gives valuable analytical data. These measurements may be made in any convenient form of calorimeter. The containing vessel for the reagents should be made of platinum or some other good conducting metal not affected by them.
The heat produced is measured in the usual way by the increment in temperature noted in the mass of water surrounding the containing [Pg 357] vessel. The determination of the heat produced in chemical reactions is a tedious and delicate operation requiring special forms of apparatus for different substances. The time element in these operations is a matter of importance, since it is necessary to work in rooms subject to slight changes of temperature and to leave the apparatus for some time at rest, in order to bring it and its contents to a uniform temperature. For these reasons the more elaborate methods of calorimetric examination are not well suited to ordinary analytical work, and the reader is referred to standard works on thermal chemistry for the details of such operations.[278] For our purpose here a description of two simple thermal processes, easily and quickly conducted, will be sufficient, while a description of the method of determining the heat of combustion of foods will be given in another place.
324. Heat of Sulfuric Saponification.—Maumené was the first to utilize the production of heat caused by mixing sulfuric acid with a fat as an analytical process.[279] In conducting the process a sulfuric acid of constant strength should be employed inasmuch as the rise of temperature produced by a strong acid is much greater than when a weaker acid is employed. The process is at best only comparative and it is evident that the total rise of temperature in any given case depends on the strength of the acid, the character, and purity of the fat or oil, the nature of the apparatus and its degree of insulation, the method of mixing and the initial temperature. For this reason the data given by different analysts vary greatly.[280] For some of the methods of conducting the operation the reader may consult the work of Allen, cited above, or other authorities.[281]
In this laboratory the process is conducted as follows:[282] The initial temperature of the reagents should be a constant one. For oils 20° is a convenient starting point and for fats about 35°, at which temperature most of them are soft enough to be easily mixed with the reagent. The acid employed should be the pure monohydrated form, specific gravity at 20°, 1.845.
The apparatus used is shown in Fig. 98. [Pg 358]

Fig. 98.—Apparatus for Determining Rise
of Temperature with Sulfuric Acid.
The test tube which holds the reagents is twenty-four centimeters in length and five in diameter. It is provided with a stopper having three perforations, one for a delicate thermometer, one for a bulb funnel for delivering the sulfuric acid, and one to guide a stirring rod bent into a spiral as shown. The thermometer is read with a magnifying glass. Fifty cubic centimeters of the fat are placed in the test tube and ten of sulfuric acid in the funnel and the apparatus is exposed at the temperature desired until all parts of it, together with the reagents, have reached the same degree. The test tube holding the oil should be placed in a vacuum-jacket tube, such as will be described in paragraph 316. The oil is allowed to run in as rapidly as possible from the funnel and the stirring rod is moved up and down two or three times [Pg 359] until the oil and acid are well mixed. Care must be exercised to stir no more than is necessary for good mixing. The mercury is observed as it ascends in the tube of the thermometer and its maximum height is noted. With the glass it is easy to read to tenths, when the thermometer is graduated in fifths of a degree. When oils are tested which produce a rise of temperature approaching 100°, in the above circumstances, (cottonseed, linseed and some others) either smaller quantities should be used or the oil diluted with some inert substance or dissolved in some inert solvent of high boiling point. For a study of the variations produced in the rise of temperature when varying proportions of oil and acid are used, the work of Munroe may be consulted.[283]
The thermélaeometer described by Jean is a somewhat complicated piece of apparatus and does not possess any advantage over the simple form described above.[284]
Instead of expressing the data obtained in thermal degrees showing the rise of temperature, Thompson and Ballentyne refer them to the heat produced in mixing sulfuric acid and water.[285]
The observed thermal degree of the oil and acid divided by that of the water and acid is termed the specific temperature reaction. For convenience in writing, this quotient is multiplied by 100. The respective quantities of acid and water are ten and fifty cubic centimeters. This method of calculation has the advantage of eliminating to a certain degree the variations which arise in the use of sulfuric acid of differing specific gravities. In the following table are given the comparative data obtained for some common oils.[286]
| Acid of 95.4 per cent. |
Acid of 96.8 per cent. |
Acid of 99 per cent. |
||||
|---|---|---|---|---|---|---|
| Kind of oil. | Rise of temp. with the oil. |
Specific temp. reaction. |
Rise of temp. with the oil. |
Specific temp. reaction. |
Rise of temp. with the oil. |
Specific temp. reaction. |
| 0° | 0° | 0° | 0° | 0° | 0° | |
| Olive oil | 36.5 | 95 | 39.4 | 85 | 44.8 | 96 |
| Rapeseed oil | 49.0 | 127 | 37.0 | 89 | 58.0 | 124 |
| Castor oil | 34.0 | 88 | ||||
| Linseed oil | 104.5 | 270 | 125.2 | 269 | ||
325. Method of Richmond.—The rise of temperature produced by [Pg 360] mixing an oil and sulfuric acid is determined by Richmond in a simple calorimeter, which is constructed by fitting a small deep beaker inside a larger one with a packing of cotton. The heat capacity of the system is determined by adding to ten grams of water, in the inner beaker, at room temperature, twenty-five grams of water of a noted higher temperature and observing the temperature of the mixture. The cooling of the system, during the time required for one determination of heat of sulfuric saponification, does not exceed one per cent of the whole number of calories produced.[287] Between the limits of ninety-two per cent and one hundred per cent the rise of temperature observed is directly proportional to the strength of the acid.
Relative Maumené Figure.—The total heat evolved per mean molecule is called by Richmond the relative maumené figure. It is calculated as follows:
| ThenM = R × | 21.5 | × | 20 + h | × | 19.5 |
| x - 78.5 | 20 | K |
326. Heat of Bromination.—The rise of temperature caused by mixing fats with sulfuric acid has long been used to discriminate between different fats and oils. Hehner and Mitchell propose a similar reaction based upon the rise of temperature produced by mixing bromin with the sample.[288] The action of bromin on unsaturated fatty bodies is instantaneous and is attended with a considerable evolution of heat. Since the action of bromin on many of the oils is very violent it is necessary to dilute the reagent with chloroform or glacial acetic acid. Owing to its high boiling point the acetic acid has some advantage over chloroform for this purpose. The tests are conveniently made in a vacuum-jacket tube. [Pg 361] In such a tube there is no loss of heat by radiation. The bromin is measured in a pipette having at its upper end a tube filled with caustic lime held between plugs of asbestos. The bromin sample to be tested and the diluent employed are kept at the same temperature before beginning the trial. They are quickly mixed and the rise of temperature noted. The oil is first dissolved in the chloroform and the bromin then added.
A somewhat constant relation is noticed between the rise of temperature and the iodin number when one gram of oil, ten cubic centimeters of chloroform and one cubic centimeter of bromin are used.
If the rise in temperature in degrees be multiplied by 5.5 the product is approximately the iodin number of the sample. Thus a sample of lard gave a rise in temperature of 10°.6 and an iodin number of 57.15. The number obtained by multiplying 10.6 by 5.5 is 58.3.
In like manner the numbers obtained for some common oils are as follows:
| Material. | Rise of temperature with bromin. |
Iodin No. | Calculated Iodin No. |
|---|---|---|---|
| Butter fat | 6.6 | 37.1 | 36.3 |
| Olive oil | 15.0 | 80.8 | 82.5 |
| Maize ” | 21.5 | 122.0 | 118.2 |
| Cotton ” | 19.4 | 107.1 | 106.7 |
| Castor ” | 15.0 | 83.8 | 82.5 |
| Linseed oil | 30.4 | 160.7 | 167.2 |
| Codliver ” | 28.0 | 144.0 | 140.0 |
327. Modification of the Heat of Bromination Method.—The method described above by Hehner and Mitchell presents many grave difficulties in manipulation, on account of the inconvenience of handling liquid bromin. The process is made practicable by dissolving both the oil or fat and the bromin in chloroform, or better in carbon tetrachlorid, in which condition the bromin solution is easily handled by means of a special pipette.[289]
In order to make a number of analyses of the same sample ten grams of the fat may be dissolved in chloroform or carbon tetrachlorid and the volume completed with the same solvent to fifty cubic centimeters. In like manner twenty cubic centimeters of the bromin are dissolved in one [Pg 362] of the solvents named and the volume completed to 100 cubic centimeters therewith.
For convenience of manipulation the solutions are thus made of such a strength that five cubic centimeters of each represent one gram of the fat and one cubic centimeter of the liquid bromin respectively.

Fig. 99. Apparatus for Determining Heat of Bromination.
The apparatus used for the work is shown in the accompanying figure. The pipette for handling the bromin solution is so arranged as to be [Pg 363] filled by the pressure of a rubber bulb, thus avoiding the danger of sucking the bromin vapor into the mouth. The filling is secured by keeping the bromin solution in a heavy erlenmeyer with a side tubulure such as is used for filtering under pressure. The solutions are mixed in a long tube, held in a larger vessel, from which the air is exhausted to secure a minimum radiation of heat. A delicate thermometer graduated in tenths serves to register the rise of temperature. The fat solution is first placed in the test tube, with care not to pour it down the sides of the tube but to add it by means of a pipette reaching nearly to the bottom. The whole apparatus having been allowed to come to a standard temperature the bromin solution is allowed to run in quickly from the pipette. No stirring is required as the liquids are sufficiently mixed by the addition of the bromin solution. The mercury in the thermometer rapidly rises and is read at its maximum point by means of a magnifying glass. With a thermometer graduated in tenths, it is easy to read to twentieths of a degree.
It is evident that the rise of temperature obtained depends on similar conditions to those mentioned in connection with sulfuric saponification. Each system of apparatus must be carefully calibrated under standard conditions and when this is done the comparative rise of temperature obtained with various oils and fats will prove of great analytical use. It is evident that the ratio of this rise of temperature to the iodin number must be determined for every system of apparatus and for every method of manipulation employed, and no fixed factor can be given that will apply in every case.
With the apparatus above described and with the method of manipulation given the following data were obtained for the oils mentioned:
| Rise of temperature. |
|
| Olive oil | 20°.5 |
| Refined cottonseed oil | 25°.7 |
| Sunflowerseed oil | 28°.4 |
| Calycanthusseed oil | 29°.0 |
Bromin and chloroform, when mixed together, give off heat, due to the chemical reaction resulting from the substitution of bromin for [Pg 364] hydrogen in the chloroform molecule and the formation of hydrobromic acid. For this reason the data obtained, when chloroform is used as a solvent, are slightly higher than with carbon tetrachlorid. The use of the latter reagent is therefore to be preferred.
328. Haloid Addition Numbers.—Many of the glycerids possess the property of combining directly with the haloids and forming thereby compounds in which the haloid, by simple addition, has become a part of the molecule. Olein is a type of this class of unsaturated glycerids. The process may take place promptly as in the case of bromin or move slowly as with iodin. The quantity of the haloid absorbed is best determined in the residual matter and not by an examination of the fat compound. By reason of the ease with which the amount of free iodin in solution can be determined, this substance is the one which is commonly employed in analytical operation on fats.
In general, the principle of the operation depends on bringing the fat and haloid together in a proper solution and allowing the addition to take place by simple contact. The quantity of the haloid in the original solution being known, the amount which remains in solution after the absorption is complete, deducted from that originally present, will give the quantity which has entered into combination with the glycerid.
329. Hübl’s Process.—In determining the quantity of iodin which will combine with a fat, the method first proposed by Hübl, or some modification thereof, is universally employed.[290] In the determination of the iodin number of a glycerid it is important that it be accomplished under set conditions and that iodid be always present in large excess. It is only when data are obtained in the way noted that they can be regarded as useful for comparison and determination. Many modifications of Hübl’s process have been proposed, but it is manifestly impracticable to give even a summary of them here. As practiced in the chemical laboratory of the Agricultural Department and by the Association of Official Agricultural Chemists, it is carried out as follows:[291]
(a). Iodin Solution.—Dissolve twenty-five grams of pure [Pg 365] iodin in 500 cubic centimeters of ninety-five per cent alcohol. Dissolve thirty grams of mercuric chlorid in 500 cubic centimeters of ninety-five per cent alcohol. The latter solution, if necessary, is filtered, and then the two solutions mixed. The mixed solution should be allowed to stand twelve hours before using.
(b). Decinormal Sodium Thiosulfate Solution.—Dissolve 24.8 grams of chemically pure sodium thiosulfate, freshly pulverized as finely as possible and dried between filter or blotting paper, and dilute with water to one liter, at the temperature at which the titrations are to be made.
(c). Starch Paste.—One gram of starch is boiled in 200 cubic centimeters of distilled water for ten minutes and cooled to room temperature.
(d). Solution of Potassium Iodid.—One hundred and fifty grams of potassium iodid are dissolved in water and the volume made up to one liter.
(e). Solution of Potassium Bichromate.—Dissolve 3.874 grams of chemically pure potassium bichromate in distilled water and make the volume up to one liter at the temperature at which the titrations are to be made.
(a). Standardizing the Sodium Thiosulfate Solution.—Place twenty cubic centimeters of the potassium bichromate solution, to which have been added ten cubic centimeters of the solution of potassium iodid, in a glass stopper flask. Add to this mixture five cubic centimeters of strong hydrochloric acid. Allow the solution of sodium thiosulfate to flow slowly into the flask until the yellow color of the liquid has almost disappeared. Add a few drops of the starch paste, and with constant shaking continue to add the sodium thiosulfate solution until the blue color just disappears. The number of cubic centimeters of thiosulfate solution used multiplied by five is equivalent to one gram of iodin. [Pg 366]
Example.—Twenty cubic centimeters of potassium bichromate solution required 16.2 sodium thiosulfate; then 16.2 × 5 = 81 = number cubic centimeters of thiosulfate solution equivalent to one gram of iodin. Then one cubic centimeter thiosulfate solution = 0.0124 gram of iodin: (Theory for decinormal solution of sodium thiosulfate, one cubic centimeter = 0.0127 gram of iodin.)
(b). Weighing the Sample.—About one gram of butter fat is placed in a glass stopper flask, holding about 300 cubic centimeters, with the precautions to be mentioned for weighing the fat for determining volatile acids.
(c). Absorption of Iodin.—The fat in the flask is dissolved in ten cubic centimeters of chloroform. After complete solution has taken place thirty cubic centimeters of the iodin solution (1) (a) are added. The flask is now placed in a dark place and allowed to stand, with occasional shaking, for three hours.
(d). Titration of the Unabsorbed Iodin.—One hundred cubic centimeters of distilled water are added to the contents of the flask, together with twenty cubic centimeters of the potassium iodid solution. Any iodin which may be noticed upon the stopper of the flask should be washed back into the flask with the potassium iodid solution. The excess of iodin is taken up with the sodium thiosulfate solution, which is run in gradually, with constant shaking, until the yellow color of the solution has almost disappeared. A few drops of starch paste are added, and the titration continued until the blue color has entirely disappeared. Toward the end of the reaction the flask should be stoppered and violently shaken, so that any iodin remaining in solution in the chloroform may be taken up by the potassium iodid solution in the water. A sufficient quantity of sodium thiosulfate solution should be added to prevent a reappearance of any blue color in the flask for five minutes.
(e). Setting the Value of the Iodin Solution by the Thiosulfate Solution.—At the time of adding the iodin solution to the fat, two flasks of the same size as those used for the determination should be employed for conducting the operation described above, but without the presence of any fat. In every other respect the performance of the blank experiments should be just as described. These blank experiments must be made each time the iodin solution is used.
Example of Blank Determinations.—Thirty cubic centimeters of [Pg 367] iodin solution required 46.4 cubic centimeters of sodium thiosulfate solution: Thirty cubic centimeters of iodin solution required 46.8 cubic centimeters of sodium thiosulfate solution: Mean, 46.6 cubic centimeters.
| Weight of fat | 1.0479 | grams | |
| Quantity of iodin solution used | 30.0 | cubic | centimeters |
| Thiosulfate equivalent to iodin used | 46.6 | ” | ” |
| Thiosulfate equivalent to remaining iodin | 14.7 | ” | ” |
| Thiosulfate equivalent to iodin absorbed | 31.9 | ” | ” |
| Percent of iodin absorbed, 31.9 × 0.0124 × 100 ÷ 1.0479 = 37.75. | |||
330. Character of Chemical Reaction.—The exact nature of the chemical process which takes place in this reaction is not definitely known. Hübl supposed that the products formed were chloro-iodid-additive compounds, and he obtained a greasy product from oleic acid, to which he ascribed the formula C₁₈H₃₄IClO₂. By others it is thought that chlorin alone may be added to the molecule.[292]
In general, it may be said that none of the glycerids capable of absorbing halogens is able to take on a quantity equivalent to theory.[293] While the saturated fatty acids (stearic series) theoretically are not able to absorb iodin some of them are found to do so to a small degree. It is evident, therefore, that it is not possible to calculate the percentage of unsaturated glycerids in a fat from their iodin number alone. According to the data worked out by Schweitzer and Lungwitz both addition and substitution of iodin take place during the reaction.[294] This fact they determined by titration with potassium iodate and iodid according to the formula 5HI + HIO₃ = 6I + 6H₂O. The authors confess that whenever free hydriodic acid is found in the mixture that iodin substitution has taken place and that for each atom of hydrogen eliminated from the fat molecule two atoms of iodin disappear, one as the substitute and the other in the form of hydriodic acid. When carbon bisulfid or tetrachlorid is used as a solvent no substitution takes place and pure additive compounds are formed.
The following process is recommended to secure a pure iodin addition to [Pg 368] a glycerid: About one gram or a little less of the oil or fat is placed in a glass stopper flask, to which are added about seven-tenths of a gram of powdered mercuric chlorid and twenty-five cubic centimeters of a solution of iodin in carbon bisulfid. The stopper is made tight by smearing it with powdered potassium iodid, tied down, and the mixture is heated for some time under pressure. By this method it is found that no hydriodic acid is formed, and hence all the iodin which disappears is added to the molecule of the glycerid. The additive numbers obtained for some oils are appended:
| Oil. | Time of heating. |
Temperature. | Per cent iodin added. |
Per cent hübl number. |
| Lard oil | 30 minutes. | 50°.0 | 73.0 | 78.4 |
| Cottonseed oil | 2 hours. | 50°.0 | 103.0 | 106.5 |
| Oleic acid | 2 ” | 65°.5 | 93.8 |
331. Solution in Carbon Tetrachlorid.—Gantter has called attention to the fact that the amount of iodin absorbed by fat does not depend alone upon the proportion of iodin present but also upon the amount of mercuric chlorid in the solution.[295] Increasing amounts of mercuric chlorid cause uniformly a much greater absorption of the iodin. For this reason he proposes to discard the use of mercuric chlorid altogether for the hübl test and to use a solvent which will at the same time dissolve both the iodin and the fat. For this purpose he uses carbon tetrachlorid. The solutions are prepared as follows:
Iodin Solution.—Ten grams of iodin are dissolved in one liter of carbon tetrachlorid.
In the preparation of this solution the iodin must not be thrown directly into the flask before the addition of the tetrachlorid. Iodin dissolves very slowly in carbon tetrachlorid and the solution is made by placing it in a sufficiently large weighing glass and adding a portion of the carbon tetrachlorid thereto. The solution is facilitated by stirring with a glass rod until the added tetrachlorid is apparently charged with the dissolved iodin. The dissolved portion is then poured into a liter flask, new portions added to the iodin and this process continued until the iodin is completely dissolved, and then sufficient additional quantities of the tetrachlorid are added to fill the flask up to the mark. [Pg 369]
332. Sodium Thiosulfate Solution.—Dissolve 19.528 grams of pure sodium thiosulfate in 1000 cubic centimeters of water. For determining the strength of the solution by titration, the solution of iodin in carbon tetrachlorid and a solution of sodium thiosulfate in water are each placed in a burette. A given volume of the iodin solution is first run into a flask with a glass stopper and afterward the sodium thiosulfate added little by little until, after a vigorous shaking, the liquid has only a little color. Some solution of starch is then added and shaken until the mixture becomes deep blue. The sodium thiosulfate solution is added drop by drop, with vigorous shaking after each addition, until the solution is completely decolorized. If both solutions have been correctly made with pure materials they will be of equal strength; that is, ten cubic centimeters of the iodin solution will be exactly decolorized by ten cubic centimeters of the sodium thiosulfate solution.
333. Method of Conducting the Absorption.—The quantity of the fat or oil employed should range from 100 to 200 milligrams, according to the absorption equivalent. These quantities should be placed in flasks with glass stoppers in the ordinary way. In the flasks are placed exactly fifty cubic centimeters of the iodin solution equivalent to 500 milligrams of iodin, and the flask is then stoppered and shaken until the fat or oil is completely dissolved. In order to avoid the volatilization of the iodin finally, sufficient water is poured into the flask to form a layer about one millimeter in thickness over the solution containing the iodin and fat. The stopper should be carefully inserted and the flask allowed to stand at rest for fifty hours.
334. Estimation of the Iodin Number.—This is determined in the usual way by titration of the amount of iodin left in excess after the absorption as above described. The iodin number is to be expressed by the number of milligrams of iodin which are absorbed by each 100 milligrams of fat.
Example.—One hundred and one milligrams of flaxseed oil were dissolved in fifty cubic centimeters of the carbon tetrachlorid solution of iodin and allowed to stand as above described for fifty [Pg 370] hours. At the end of this time, 42.3 cubic centimeters of the sodium thiosulfate solution were required to decolorize the excess of iodin remaining.
Statement of Results.—Fifty cubic centimeters of the sodium thiosulfate equal 500 milligrams of iodin; therefore, 42.3 cubic centimeters of the thiosulfate solution equal 423 milligrams of iodin. The difference equals seventy-seven milligrams of iodin absorbed by 101 milligrams of the flaxseed oil. Therefore, the iodin number equivalent and the milligrams of iodin absorbed by 100 milligrams of flaxseed oil equal 76.2.
It is evident from the above determination that the iodin number of the oil, when obtained in the manner described, is less than half that secured by the usual hübl process. Since the solvent employed, however, is more stable than chloroform when in contact with iodin or bromin, the proposed variation is one worthy of the careful attention of analysts.
McIlhiney has called especial attention to the low numbers given by the method of Gantter, and from a study of the data obtained concludes that iodin alone will not saturate glycerids, no matter what the solvents may be.[296]
It is clear, therefore, that the process of Gantter cannot give numbers which are comparable with those obtained by the usual iodin method. Any comparative value possessed by the data given by the process of Gantter must be derived by confining it to the numbers secured by the carbon tetrachlorid process alone.
335. Substitution of Iodin Monochlorid for Hübl’s Reagent.—Ephraim has shown that iodin monochlorid may be conveniently substituted for the hübl reagent with the advantage that it can be safely used at once, while the hübl reagent undergoes somewhat rapid changes when first prepared. The present disadvantage of the process is found in the fact that the iodin monochlorid of commerce is not quite pure and each new lot requires to be titrated for the determination of its purity.
The reagent is prepared of such a strength as to contain 16.25 grams of iodin monochlorid per liter. The solvent used is alcohol. The operation is carried out precisely as in the hübl method, substituting the alcoholic solution of iodin monochlorid for the iodin reagent proposed [Pg 371] by Hübl.[297] If the iodin monochlorid solution, after acting on the oil, be titrated without previous addition of potassium iodid a new value is obtained, the chloriodin number. In titrating, the sodium thiosulfate is added until the liquid, which is made brown by the separated iodin, becomes yellow. At this point the solution is diluted, starch paste added, and the titration completed.
336. Preservation of the Hübl Reagent.—To avoid the trouble due to changes in the strength of Hübl’s reagent, Mahle adds hydrochloric acid to it at the time of its preparation.[298] The reagent is prepared as follows: Twenty-five grams of iodin dissolved in a quarter of a liter of ninety-five per cent alcohol are mixed with the same quantity of mercuric chlorid in 200 cubic centimeters of alcohol, the same weight of hydrochloric acid of 1.19 specific gravity added and the volume of the mixture completed to half a liter with alcohol. After five days such a solution gave, on titration, 49.18 instead of 49.31 grams per liter of iodin.
It will be observed that this solution is double the usual strength, but this does not influence the accuracy of the analytical data obtained. It appears that the hübl number is not, therefore, an iodin number, but expresses the total quantity of iodin, chlorin and oxygen absorbed by the fat during the progress of the reaction.
337. Bromin Addition Number.—In the process of Hübl and others an attempt is made to determine the quantity of a halogen, e.g., iodin, which the oil, fat or resin will absorb under certain conditions. The numbers obtained, however, represent this absorption only approximately, because the halogen may disappear through substitution as well as absorption. Whether or not a halogen is added, i. e., absorbed or substituted, may be determined experimentally.
The principle on which the determination depends rests on the fact that a halogen, e. g., bromin, forms a molecule of hydrobromic acid for every atom of bromin substituted, while in a simple absorption of the halogen no such action takes place. If, therefore, bromin be brought into contact with a fat, oil or resin, the determination of the [Pg 372] quantity of hydrobromic acid formed will rigidly determine the quantity of bromin substituted during the reaction. If this quantity be deducted from the total bromin which has disappeared, the relative quantities of the halogen added and substituted are at once determined. In the method of McIlhiney[299] bromin is used instead of iodin because the addition figures of iodin are in general much too low.
The Reagents.—The following solutions are employed:
1. One-third normal bromin dissolved in carbon tetrachlorid:
2. One-tenth normal sodium thiosulfate:
3. One-tenth normal potassium hydroxid.
The Manipulation.—From a quarter to one gram of the fat, oil or resin, is dissolved in ten cubic centimeters of carbon tetrachlorid in a dry bottle of 500 cubic centimeters capacity, provided with a well-ground glass stopper. An excess of the bromin solution is added, the bottle tightly stoppered, well shaken and placed in the dark. At the end of eighteen hours the bottle is placed in a freezing mixture and cooled until a partial vacuum is formed. A piece of wide rubber tubing an inch and a half long is slipped over the lip of the bottle so as to form a well about the stopper. This well having been filled with water the stopper is lifted and the water is sucked into the bottle absorbing all the hydrobromic acid which has been formed. The well should be kept filled with water, as it is gradually taken in until in all twenty-five cubic centimeters have been added. The bottle is next well shaken and from ten to twenty cubic centimeters of a twenty per cent potassium iodid solution added.
The excess of bromin liberates a corresponding amount of iodin, which is determined by the thiosulfate solution in the usual way, after adding about seventy-five cubic centimeters of water. The total bromin which has disappeared is then calculated from the data obtained, the strength of the original bromin solution having been previously determined. The contents of the bottle are next transferred to a separatory funnel, the aqueous portion separated, filtered through a linen filter, a few drops of thiosulfate solution added, if a blue color persist, and the free hydrobromic acid determined by titration with potassium hydroxid, using methyl orange as indicator. The end [Pg 373] reaction is best observed by placing the solution in a porcelain dish, adding the alkali in slight excess, and titrating back with tenth-normal hydrochloric acid until the pink tint is perceived. From the number of cubic centimeters of alkali used the amount of bromin present as hydrobromic acid is calculated, and this expressed as percentage gives the bromin substitution figure. The bromin substitution figure multiplied by two and subtracted from the total absorption gives the addition figure.
Following are the data for some common substances:
| Substance. | Total bromin absorption in eighteen hours. |
Bromin addition figure. |
Bromin substitution figure. |
||
|---|---|---|---|---|---|
| Rosin | 212.70 | 0.00 | 106.35 | ||
| Raw | linseed | oil | 102.88 | 102.88 | 00.00 |
| Boiled | ” | ” | 103.92 | 103.92 | 00.00 |
| Salad | cotton | ” | 65.54 | 64.26 | 0.64 |
| Sperm | ” | 56.60 | 54.52 | 1.04 | |
By the process just described it is possible to detect mixtures of rosins and rosin oils with animal and vegetable oils. In this respect it possesses undoubted advantages over the older methods.
338. Method Of Hehner.—The absorption of bromin which takes place when unsaturated fats are brought into contact with that reagent was made the basis of an analytical process, proposed by Allen as long ago as 1880.[300] In the further study of the phenomena of bromin absorption, as indicated by McIlhiney, Hehner modified the method as indicated below.[301] From one to three grams of the sample are placed in a tared wide-mouthed flask and dissolved in a little chloroform. Bromin is added to the solution, drop by drop, until it is in decided excess. The flask is placed on a steam-bath and heated until the greater part of the bromin is evaporated, when some more chloroform is added and the heating continued until all the free bromin has escaped. The flask is put in a bath at 125° and dried to constant weight. A little acrolein and hydrobromic acid escape during the drying and the residue may be colored, or a heavy bromo oil be obtained. The gain in weight [Pg 374] represents the bromin absorbed. The bromin number may be converted into the iodin number by multiplying by 1.5875.[302]

Fig. 100.—
Olein
Tube.
339. Halogen Absorption and Addition of Fat Acids.—Instead of employing the natural glycerids for determining the degree of action with the halogens the acids may be separated by some of the processes of saponification hereafter described and used as directed for the glycerids themselves. It is doubtful if any practical advantage arises from this variation of the process. If the fat acids be separated, however, it is possible to get some valuable data from the halogen absorption of the fractions. Theoretically the stearic series of acids would suffer no change in contact with halogens while the oleic series is capable of a maximum absorptive and additive action. On this fact is based a variation of the iodin process in which an attempt is made to separate the oleic acid from its congeners and to apply the halogen to the separated product.
The method of separation devised by Muter is carried out as follows:[303] The separatory or olein tube consists of a wide burette stem, provided with a lateral stopcock, and drawn out below to secure a clamp delivery tube, and at the top expanded into a bulb closed with a ground glass stopper, as shown in Fig. 100. Forty cubic centimeters of liquid are placed in the tube and the surface is marked 0. Above this the graduation is continued in cubic centimeters to 250, which figure is just below the bulb at the top.
The process of analysis is conducted as follows: About three grams of the oil or fat are placed in a flask, with fifty cubic centimeters of alcoholic potash lye, containing enough potassium hydroxid to ensure complete saponification. The flask is closed and heated on a water-bath until saponification is complete. The pressure flask to be described hereafter may be conveniently used. After cooling, the excess of alkali is neutralized with acetic acid in presence of phenolphthalien and then alcoholic potash added until a faint pink color is produced. In a large porcelain dish place 200 cubic centimeters of water and thirty of a ten per cent solution of lead acetate and boil. Pour slowly, with constant [Pg 375] stirring, into the boiling liquid the soap solution prepared as above described, and allow to cool, meanwhile continuing the stirring. At the end, the liquid remaining is poured off and the solid residue washed with hot water by decantation.
The precipitate of lead salts is finally removed from the dish into a stoppered bottle, the dish washed with pure ether, the washings added to the bottle together with enough ether to make the total volume thereof 120 cubic centimeters. The closed bottle is allowed to stand for twelve hours with occasional shaking, by which time the lead oleate will have been completely dissolved. The insoluble lead salts are next separated by filtration, and the filtrate collected in the olein tube. The washing is accomplished by ether and, to avoid loss, the funnel is covered with a glass plate. The ethereal solution of lead oleate is decomposed by dilute hydrochloric acid, using about forty cubic centimeters of a mixture containing one part of strong acid to four of water. The olein tube is closed and shaken until the decomposition is complete, which will be indicated by the clearing of the ethereal solution. The tube is allowed to remain at rest until the liquids separate and the aqueous solution is run out from the pinch-cock at the lower end. The residue is washed with water by shaking, the water drawn off as just described, and the process continued until all acidity is removed.
Water is then added until the separating plane between the two liquids is at the zero of the graduation, and enough ether added to make the ethereal solution of a desired volume, say 200 cubic centimeters. After well mixing, the ethereal solution or an aliquot part thereof, e.g., fifty cubic centimeters, is removed by the side tubulure and nearly the whole of the ether removed from the portion by distillation. To the residue are added fifty cubic centimeters of pure alcohol and the solution is titrated for oleic acid with decinormal sodium hydroxid solution. Each cubic centimeter of the hydroxid solution used is equivalent to 0.0282 gram of oleic acid. The total quantity of oleic acid contained in the amount of fat used is readily calculated from the data obtained. [Pg 376]
To determine the iodin absorption of the free acid another measured quantity of the ethereal solution containing as nearly as possible half a gram of oleic acid, is withdrawn from the olein tube, and the ether removed in an atmosphere of pure carbon dioxid. To the residue, without allowing it to come in contact with the air, fifty cubic centimeters of Hübl’s reagent are added and the flask put aside in the dark for twelve hours. At the end of this time thirty-five cubic centimeters of a ten per cent solution of potassium iodid are added, the contents of the flask made up to a quarter of a liter with water, fifteen cubic centimeters of chloroform added, and the excess of iodin titrated in the way already described. The percentage of iodin absorbed is calculated as already indicated.
Lane has proposed a more rapid process for the above determination.[304] The lead soaps are precipitated in a large erlenmeyer and cooled rapidly in water, giving the flask meanwhile a circular motion which causes the soaps to adhere to its walls. Wash with hot water, rinsing once with alcohol, add 120 cubic centimeters of ether, attach a reflux condenser, and boil until the lead oleate is dissolved, cool slowly, to allow any lead stearate which has passed into solution to separate, and filter into the olein tube. The rest of the operation is conducted as described above. The percentage of oleic acid and its iodin absorption in the following glycerids are given in the table below:
| Cottonseed oil. |
Lard. | Peanut oil. | |
| Per cent oleic acid | 75.16 | 64.15 | 79.84 |
| Per cent iodin absorbed | 141.96 | 99.48 | 114.00 |
340. Saponification.—In many of the analytical operations which are conducted on the glycerids it is necessary to decompose them. When this is accomplished by the action of a base which displaces the glycerol from its combination with the fat acids, the resulting salts are known as soaps and the process is named saponification. In general use the term saponification is applied, not only strictly, as above defined, but also broadly, including the setting free of the glycerol either by the action of strong acids or by the application of superheated steam. In chemical processes the saponification of a [Pg 377] glycerid is almost always accomplished by means of soda or potash lye. This may be in aqueous or alcoholic solution and the process is accomplished either hot or cold, in open vessels or under pressure. It is only important that the alkali and glycerid be brought into intimate contact. The rate of saponification is a function of the intimacy of contact, the nature of the solvent and the temperature. For chemical purposes, it is best that the decomposition of the glycerid be accomplished at a low temperature and for most samples this is secured by dissolving the alkali in alcohol.
In respect of solvents, that one would be most desirable, from theoretical considerations, which acts on both the glycerids and alkalies. In the next rank would be those which dissolve one or the other of the materials and are easily miscible, as, for instance, carbon tetrachlorid for the glycerid and alcohol for the alkali. As a rule, the glycerid is not brought into solution before the saponification process is commenced. Instead of using an alcoholic solution of sodium or potassium hydroxid the sodium or potassium alcoholate may be employed, made by dissolving metallic sodium or potassium in alcohol. It is probable, however, that a little water is always necessary to complete the process.
If a fat be dissolved in ether and treated with sodium alcoholate, a granular deposit of soap is soon formed and the saponification is completed in twenty-four hours. As much as 150 grams of fat can be saponified with ten grams of metallic sodium dissolved in 250 cubic centimeters of absolute alcohol.[305] For practical purposes the alcoholic solution of the hydroxid is sufficient.
The chemical changes which fats undergo on saponification are of a simple kind. When the process is accomplished by means of alkalies, the alkaline base takes the place of the glycerol as indicated in the following equation:
| Triolein 884. | Potassium hydroxid 168. |
||
| C₃H₅(O.C₁₈H₃₃O)₃ | + | 3KOH | = |
| Potassium oleate 960. |
Glycerol 92. | ||
| (KO.C₁₈H₃₃O)₃ | + | C₃H₅(OH)₃. | |
The actual changes which take place in ordinary saponification are not so simple, however, since natural glycerids are mixtures of several widely differing fats, each of which has its own rate of [Pg 378] decomposition. Palmitin and stearin, for instance, are saponified more readily than olein and some of the saponifiable constituents of resins and waxes are extremely resistant to the action of alkalies. The above equation may be regarded as typical for saponification in aqueous or alcoholic solutions in open dishes or under pressure. If the alkali used be prepared by dissolving metallic sodium or potassium in absolute alcohol (sodium alcoholate or ethoxid) the reaction which takes place is probably represented by the equation given below:
C₃H₅(O.C₁₈H₃₃O)₃ + 3C₂H₅.ONa = C₃H₅(ONa)₃ + 3C₁₈H₃₃O.O.C₂H₅,
in which it is seen that complete saponification cannot occur without the absorption of some water, by which the sodium glyceroxid is converted into glycerol and sodium hydroxid, the latter compound eventually uniting with the ethyl ether of the fat acid.[306]
Glycerids are decomposed when heated with water under a pressure of about sixteen atmospheres or when subjected to a current of superheated steam at 200°. The reaction consists in the addition of the elements of water, whereby the glyceryl radicle is converted into free glycerol and the fat acid is set free. The chemical change which ensues is shown below:
C₃H₅(O.C₁₈H₃₃O)₃ + 3H₂O = 3C₁₈H₃₄O₂ + C₃H₅(OH)₃.
The details of saponification with sulfuric acid are of no interest from an analytical point of view.[307]
341. Saponification in an Open Dish.—The simplest method of saponifying fats is to treat them with the alkaline reagent in an open dish. In all cases the process is accelerated by the application of heat. Vigorous stirring also aids the process by securing a more intimate mixture of the ingredients. This method of decomposing glycerids, however, is not applicable in cases where volatile ethers may be developed. These ethers may escape saponification and thus prevent the formation of the maximum quantity of soap. While not suited to exact quantitive work, the method is convenient in the preparation of fat acids which are to be the basis of subsequent analytical [Pg 379] operations, as, for instance, in the preparation of fat acids for testing with silver nitrate. Large porcelain dishes are conveniently used and the heat is applied in any usual way, with care to avoid scorching the fat.
342. Saponification under Pressure.—The method of saponification which has given the best satisfaction in my work and which has been adopted by the Association of Official Agricultural Chemists is described below.[308]
Reagents.—The reagents employed are a solution of pure potash containing 100 grams of the hydroxid dissolved in fifty-eight grams of recently boiled distilled water, alcohol of approximately ninety-five per cent strength redistilled over caustic soda, and sodium hydroxid solution prepared as follows:
One hundred grams of sodium hydroxid are dissolved in 100 cubic centimeters of distilled water. The caustic soda should be as free as possible from carbonates, and be preserved from contact with the air.
Apparatus.—A saponification flask; it has a round bottom and a ring near the top, by means of which the stopper can be tied down. The flask is arranged for heating as shown in Fig. 101. A pipette graduated to deliver forty cubic centimeters is recommended as being more convenient than a burette for measuring the solutions: A pipette with a long stem graduated to deliver 5.75 cubic centimeters at 50°.
Manipulation.—The fat to be examined should be melted and kept in a dry warm place at about 60° for two or three hours, until the water has entirely separated. The clear supernatant fat is poured off and filtered through a dry filter paper in a jacket funnel containing boiling water. Should the filtered fat, in a fused state, not be perfectly clear, it must be filtered a second time. The final drying is accomplished at 100° in a thin layer in a flat bottom dish, in partial vacuum or an atmosphere of inert gas.
The saponification flasks are prepared by thoroughly washing with water, alcohol, and ether, wiping perfectly dry on the outside, and heating for one hour at the temperature of boiling water. The hard flasks used in moist combustions with sulfuric acid for the [Pg 380] determination of nitrogen are well suited for this work. The flasks should be placed in a tray by the side of the balance and covered with a silk handkerchief until they are perfectly cool. They must not be wiped with a silk handkerchief within fifteen or twenty minutes of the time they are weighed or else the electricity developed will interfere with weighing. The weight of the flasks having been accurately determined, they are charged with the melted fat in the following way:

Fig. 101.—Apparatus for Saponifying under Pressure.
The pipette with a long stem, marked to deliver 5.75 cubic centimeters, is warmed to a temperature of about 50°. The fat, having been poured back and forth once or twice into a dry beaker in order to thoroughly mix it, is taken up in the pipette, the nozzle of the pipette having been previously wiped to remove any externally adhering fat, is carried to near the bottom of the flask and 5.75 cubic centimeters of fat allowed to flow into the flask. After the flasks have been charged in [Pg 381] this way they should be re-covered with the silk handkerchief and allowed to stand for fifteen or twenty minutes, when they are again weighed.
343. Methods of Saponification.—In the Presence of Alcohol.—Ten cubic centimeters of ninety-five per cent alcohol are added to the fat in the flask, and then two cubic centimeters of the sodium hydroxid solution. A soft cork stopper is inserted and tied down with a piece of twine. The saponification is completed by placing the flask upon the water or steam-bath. The flask during the saponification, which should last one hour, should be gently rotated from time to time, being careful not to project the soap for any distance up its sides. At the end of an hour the flask, after having been cooled to near the room temperature, is opened.
Without the Use of Alcohol.—To avoid the danger of loss from the formation of ethers, and the trouble of removing the alcohol after saponification, the fat may be saponified with a solution of caustic potash in a closed flask without using alcohol. The operation is carried on exactly as indicated above for saponification in the presence of alcohol, using potassium instead of sodium hydroxid solution. For the saponification, use two cubic centimeters of the potassium hydroxid solution which are poured on the fat after it has solidified in the flask. Great care must be taken that none of the fat be allowed to rise on the sides of the saponifying flask to a point where it cannot be reached by the alkali. During the process of saponification the flask can only be very gently rotated in order to avoid the difficulty mentioned. This process is not recommended with any apparatus except a closed flask with round bottom. Potash is used instead of soda so as to form a softer soap and thus allow a more perfect saponification.
The saponification may also be conducted as follows: The alkali and fat in the melted state are shaken vigorously in the saponification flask until a complete emulsion is secured. The rest of the operation is then conducted as above.
344. Saponification in the Cold.—By reason of the danger of loss from volatile ethers in the hot alcoholic saponification, a method [Pg 382] for successfully conducting the operation in the cold is desirable. Such a process has been worked out by Henriques.[309] It is based upon the previous solution of the fat in petroleum ether, in which condition it is so easily attacked by the alcoholic alkali as to make the use of heat during the saponification unnecessary. The process is conveniently conducted in a porcelain dish covered with a watch glass. Five grams of the fat are dissolved in twenty-five cubic centimeters of petroleum ether and treated with an equal quantity of four per cent alcoholic soda lye. The process of saponification begins at once and is often indicated by the separation of sodium salts. It is best to allow the action to continue over night and, with certain difficultly saponifiable bodies, such as wool fat and waxes, for twenty-four hours. In the case of butter fat an odor of butyric ether may be perceived at first but it soon disappears. After the saponification is complete, the excess of alkali is determined by titration in the usual way with set hydrochloric acid, using phenolphthalien as indicator. For the determination of volatile acids, the mixture, after saponification is complete, is evaporated rapidly to dryness, the solid matter being reduced to powder with a glass rod, after which it is transferred to a distilling flask and the volatile acids secured by the usual processes. In comparison with the saponification and reichert-meissl numbers obtained with hot alcoholic potash, the numbers given by the cold process are found to be slightly higher with those fats which give easily volatile ethers. On account of the simplicity of the process and the absence of danger of loss from ethers, it is to be recommended instead of the older methods in case a more extended trial of it should establish the points of excellence claimed above.
345. Saponification Value.—The number of milligrams of potassium hydroxid required to completely saturate one gram of a fat is known as the saponification value of the glycerid. The process of determining this value, as worked out by Koettstorfer and modified in the laboratory of the Department of Agriculture, is as follows:[310]
[Pg 383] The saponification is accomplished with the aid of potassium hydroxid and in the flask and manner described in the preceding paragraph. About two grams of the fat will be found a convenient quantity. Great care must be exercised in measuring the alkaline solution, the same pipette being used in each case and the same time for draining being allowed in every instance. Blanks are always to be conducted with each series of examinations. As soon as the saponification is complete, the flask is removed from the bath, allowed to cool and its contents are titrated with seminormal hydrochloric acid and phenolphthalien as indicator. The number expressing the saponification value is obtained by subtracting the number of cubic centimeters of seminormal hydrochloric acid required to neutralize the alkali after saponification from that required to neutralize the alkali of the blank determinations, multiplying the result by 28.06 and dividing the product by the number of grams of fat employed.
Example.—Weight of sample of fat used 1.532 grams: Number of cubic centimeters half normal hydrochloric acid required to saturate blank, 22.5: Number of cubic centimeters of half normal hydrochloric acid required to saturate the alkali after saponification 12.0: Difference, 10.5 cubic centimeters:
Then 10.50 × 28.06 ÷ 1.532 = 192.3.
This latter number represents the saponification value of the sample.
346. Saponification Equivalent.—Allen defines the saponification equivalent as the number of grams of fat saponified by one equivalent, viz., 56.1 grams of potassium hydroxid.[311] The saponification equivalent is readily calculated from the saponification value using it as a divisor and 56100 as a dividend. Conversely the saponification value may be obtained by dividing 56100 by the saponification equivalent. No advantage is gained by the introduction of a new term so nearly related to saponification value.
347. Saponification Value of Pure Glycerids.—The theoretical [Pg 384] saponification values of pure glycerids are given in the following table.[312]
| Name. | Symbol. | Molecular weight. |
Saponification value. |
|---|---|---|---|
| Butyrin | C₃H₅(O.C₄H₇O)₃ | 302 | 557.3 |
| Valerin | C₃H₅(O.C₅H₉O)₃ | 344 | 489.2 |
| Caproin | C₃H₅(O.C₆H₁₁O)₃ | 386 | 438.3 |
| Caprin | C₃H₅(O.C₁₀H₁₉O)₃ | 554 | 305.0 |
| Laurin | C₃H₅(O.C₁₂H₂₃O)₃ | 638 | 263.8 |
| Myristin | C₃H₅(O.C₁₄H₂₇O)₃ | 722 | 233.1 |
| Palmitin | C₃H₃(O.C₁₆H₃₁O)₃ | 806 | 208.8 |
| Stearin | C₃H₅(O.C₁₈H₃₅O)₃ | 890 | 189.1 |
| Olein | C₃H₅(O.C₁₈H₃₃O)₃ | 884 | 190.4 |
| Linolein | C₃H₅(O.C₁₈H₃₁O)₃ | 878 | 191.7 |
| Ricinolein | C₃H₅(O.C₁₈H₃₃O₂)₃ | 932 | 180.6 |
| Euricin | C₃H₅(O.C₂₂H₁₄O)₃ | 1052 | 160.0 |
From the above table it is seen that in each series of glycerids the saponification equivalent falls as the molecular weight rises.
348. Acetyl Value.—Hydroxy acids and alcohols, when heated with glacial acetic acid, undergo a change which consists in substituting the radicle of acetic acid for the hydrogen atom of the alcoholic hydroxyl group. This change is illustrated by the equations below:[313]
For a Fat Acid:
| Ricinoleic acid. | Acetic anhydrid. | ||
| C₁₇H₃₂(OH).COOH | + | (C₂H₃O)₂O | = |
| Acetyl-ricinoleic acid. | Acetic acid. | ||
| C₁₇H₃₂(O.C₂H₃O)COOH | + | HC₂H₃O₂. | |
For an Alcohol:
| Cetyl alcohol. | Acetic anhydrid. | ||
| C₁₆H₃₃.OH | + | (C₂H₃O)₂O | = |
| Cetyl acetate. | Acetic acid. | ||
| C₁₆H₃₃.C₂H₃O | + | HC₂H₃O₂. | |
Determination.—The method of determining the acetyl value of a fat or alcohol has been described by Benedikt and Ulzer.[314] The operation is conducted on the fat acids and not on the glycerids containing them.
The insoluble fat acids are prepared as directed in paragraph 340.
From twenty to fifty grams of the fat acids are boiled with an equal volume of acetic anhydrid, in a flask with a reflux condenser, for two hours. The contents of the flask are transferred to a larger vessel of [Pg 385] about one liter capacity, mixed with half a liter of water and boiled for half an hour. To prevent bumping, some bubbles of carbon dioxid are drawn through the liquid by means of a tube drawn out to a fine point and extending nearly to the bottom of the flask. The liquids are allowed to separate into two layers and the water is removed with a syphon. The oily matters are treated several times with boiling water until the acetic acid is all washed out. The acetylated fat acids are filtered through a dry hot jacket filter and an aliquot part, from three to five grams, is dissolved in absolute alcohol. After the addition of phenolphthalien the mixture is titrated as in the determination of the saponification value. The acid value thus obtained is designated as the acetyl acid value. A measured quantity of alcoholic potash, standardized by seminormal hydrochloric acid, is added, the mixture boiled and the excess of alkali determined by titration. The quantity of alkali consumed in this process measures the acetyl value. The sum of the acetyl acid and the acetyl values is the acetyl saponification value. The acetyl value is therefore equal to the difference of the saponification and acid values of the acetylated fat acids. In other words, the acetyl value indicates the number of milligrams of potassium hydroxid required to neutralize the acetic acid obtained by the saponification of one gram of the acetylated fat acids.
Example.—A portion of the fat acids acetylated as described, weighing 3.379 grams, is exactly neutralized by 17.2 cubic centimeters of seminormal potassium hydroxid solution, corresponding to 17.2 × 0.02805 = 0.4825 gram of the hydroxid, hence 0.4825 × 1000 ÷ 3.379 = 142.8, the acetyl acid value of the sample.
After the addition of 32.8 cubic centimeters more of the seminormal potash solution, the mixture is boiled to saponify the acetylated fat acids. The residual potash requires 14.2 cubic centimeters of seminormal hydrochloric acid. The quantity of potash required for the acetic acid is therefore 32.8 - 14.3 = 18.5 cubic centimeters or 18.5 × 0.02805 = 0.5189 gram of potassium hydroxid. Then 0.5189 × 1000 ÷ 3.379 = 153.6 = acetyl value of sample. The sum of these two values, viz., 142.8 and 153.6 is 296.4, which is the acetyl [Pg 386] saponification value of the sample. As with the iodin numbers, however, it is also found that acids of the oleic series give an acetyl value when treated as above, and it has been proposed by Lewkowitsch to determine, in lieu of the data obtained, the actual quantity of acetic acid absorbed by fats.[315] This is accomplished by saponifying the acetylated product with alcoholic potash and determining the free acetic acid by distillation, in a manner entirely analogous to that used for estimating volatile fat acids described further on.
The rôle which the acetyl value plays in analytical determinations is interesting, but the data it gives are not to be valued too highly.
349. Determination of Volatile Fat Acids.—The fat acids which are volatile at the temperature of boiling water, consist chiefly of butyric and its associated acids occurring in the secretions of the mammary glands. Among vegetable glycerids cocoanut oil is the only common one which has any notable content of volatile acids. The boiling points of the above acids, in a pure state, are much higher than the temperature of boiling water; for instance, butyric acid boils at about 162°. By the expression volatile acids, in analytical practice, is meant those which are carried over at 100°, or a little above, with the water vapor, whatever be their boiling point. The great difficulty of removing the volatile from the non-volatile fat acids has prevented the formulation of any method whereby a sharp and complete separation can be accomplished. The analyst, at the present time, must be content with some approximate process which, under like conditions, will give comparable results. Instead, therefore, of attempting a definite determination, he confines his work to securing a partial separation and in expressing the degree of volatile acidity in terms of a standard alkali. To this end, a definite weight of the fat is saponified, the resulting soap decomposed with an excess of fixed acid, and a definite volume of distillate collected and its acidity determined by titration with decinormal alkali. The weight of fat operated on is either two and a half[316] or five grams.[317]
Numerous minor variations have been proposed in the process, the most important of which is in the use of phosphoric instead of sulfuric acid [Pg 387] in the distillation. An extended experience with both acids has shown that no danger is to be apprehended in the use of sulfuric acid and that on the whole it is to be preferred to phosphoric.[318]
The process as used in this laboratory and as adopted by the official agricultural chemists is conducted as follows:[319]
350. Removal of the Alcohol.—The saponification is accomplished in the manner already described, (341-344) and when alcoholic potash is used proceed as follows:
The stopper having been laid loosely in the mouth of the flask, the alcohol is removed by dipping the flask into a steam-bath. The steam should cover the whole of the flask except the neck. After the alcohol is nearly removed, frothing may be noticed in the soap, and to avoid any loss from this cause or any creeping of the soap up the sides of the flask, it should be removed from the bath and shaken to and fro until the frothing disappears. The last traces of alcohol vapor may be removed from the flask by waving it briskly, mouth down, to and fro.
Dissolving the Soap.—After the removal of the alcohol the soap should be dissolved by adding 100 cubic centimeters of recently boiled distilled water, or eighty cubic centimeters when aqueous potassium hydroxid has been used for saponification, and warming on the steam-bath, with occasional shaking, until the solution of the soap is complete.
Setting free the Fat Acids.—When the soap solution has cooled to about 60° or 70°, the fat acids are separated by adding forty cubic centimeters of dilute sulfuric acid solution containing twenty-five grams of acid in one liter, or sixty cubic centimeters when aqueous potassium hydroxid has been used for saponification.
Melting the Fat Acid Emulsion.—The flask is restoppered as in the first instance and the fat acid emulsion melted by replacing the flask on the steam-bath. According to the nature of the fat examined, the time required for the fusion of the fatty acid emulsions may vary from a few minutes to several hours.
The Distillation.—After the fat acids are completely melted, which can be determined by their forming a transparent, oily layer on [Pg 388] the surface of the water, the flask is cooled to room temperature, and a few pieces of pumice stone added. The pumice stone is prepared by throwing it, at a white heat, into distilled water, and keeping it under water until used. The flask is connected with a glass condenser, Fig. 102, slowly heated with a naked flame until ebullition begins, and then the distillation continued by regulating the flame in such a way as to collect 110 cubic centimeters of the distillate in, as nearly as possible, thirty minutes. The distillate should be received in a flask accurately marked at 110 cubic centimeters.

Fig. 102.—Apparatus for the Distillation of Volatile Acids.
Titration of the Volatile Acids.—The 110 cubic centimeters of distillate, after thorough mixing, are filtered through perfectly dry filter paper, 100 cubic centimeters of the filtered distillate poured into a beaker holding about a quarter of a liter, half a cubic centimeter of phenolphthalien solution added and decinormal barium hydroxid solution run in until a red color is produced. The contents of the beaker are then returned to the measuring flask to remove any acid remaining therein, poured again into the beaker, and the titration continued until the red color produced remains apparently unchanged for two or three minutes, The number of cubic centimeters of decinormal [Pg 389] barium hydroxid solution required should be increased by one-tenth to represent the entire distillate.
The number thus obtained expresses, in cubic centimeters of decinormal alkali solution, the volatile acidity of the sample. In each case blank distillations of the reagents used should be conducted under identical conditions, especially when alcoholic alkali is used for saponification. It is difficult to secure alcohol which will not yield a trace of volatile acid in the conditions named. The quantity of decinormal alkali required to neutralize the blank distillate is to be deducted from that obtained with the sample of fat.
351. Determination of Soluble and Insoluble Fat Acids.—The volatile fat acids are more or less soluble in water, while those which are not distillable in a current of steam are quite insoluble. It is advisable, therefore, to separate these two classes of fat acids, and the results thus obtained are perhaps more decidedly quantitive than are given by the distillation process just described. The methods used for determining the percentage of insoluble acids are essentially those of Hehner.[320] Many variations of the process have been proposed, especially in respect of the soluble acids.[321]
The process, as conducted in this laboratory and approved by the Association of Official Agricultural Chemists, is as follows:
Preparation of Reagents.—Sodium Hydroxid Solution.—A decinormal solution of sodium hydroxid is used. Each cubic centimeter contains 0.0040 gram of sodium hydroxid and neutralizes 0.0088 gram of butyric acid (C₄H₈O₂).
Alcoholic Potash Solution.—Dissolve forty grams of good caustic potash in one liter of ninety-five per cent alcohol redistilled over caustic potash or soda. The solution must be clear and the potassium hydroxid free from carbonates.
Standard Acid Solution.—Prepare accurately a half normal solution of hydrochloric acid.
Indicator.—Dissolve one gram of phenolphthalien in 100 cubic centimeters of ninety-five per cent alcohol.
Determination.—Soluble Acids.—About five grams of the sample are placed in the saponification flask already described, fifty cubic [Pg 390] centimeters of the alcoholic potash solution added, the flask stoppered and placed in the steam-bath until the fat is entirely saponified. The operation may be facilitated by occasional agitation. The alcoholic potash is always measured with the same pipette and uniformity further secured by allowing it to drain the same length of time (thirty seconds). Two or three blank experiments are conducted at the same time.
In from five to thirty minutes, according to the nature of the fat, the liquid will appear perfectly homogeneous and, when this is the case, the saponification is complete and the flask is removed and cooled. When sufficiently cool, the stopper is removed and the contents of the flask rinsed with a little ninety-five per cent alcohol into an erlenmeyer, of about 200 cubic centimeters capacity, which is placed on the steam-bath together with the blanks until the alcohol is evaporated.
The blanks are titrated with half normal hydrochloric acid, using phenolphthalien as indicator, and one cubic centimeter more of the half normal hydrochloric acid than is required to neutralize the potash in the blanks is run into each of the flasks containing the fat acids. The flask is connected with a reflux condenser and placed on the steam-bath until the separated fat acids form a clear stratum on the upper surface of the liquid. The flask and contents are cooled in ice-water.
The fat acids having quite solidified, the liquid contents of the flask are poured through a dry filter into a liter flask, taking care not to break the cake. Between 200 and 300 cubic centimeters of water are brought into the flask, the cork with the condenser reinserted and the flask placed on the steam-bath until the cake of acid is thoroughly melted. During the melting of the cake of fat acids, the flask should occasionally be agitated with a rotary motion in such a way that its contents are not made to touch the cork. When the fat acids have again separated into an oily layer, the flask and its contents are cooled in ice-water and the liquid filtered through the same filter into the same liter flask as before. This treatment with hot water, followed by cooling and filtration of the wash water, is repeated three times, the washings being added to the first filtrate. The mixed washings and [Pg 391] filtrate are made up to one liter, and 100 cubic centimeters thereof in duplicate are titrated with decinormal sodium hydroxid. The number of cubic centimeters of sodium hydroxid required for each 100 cubic centimeters of the filtrate is multiplied by ten. The number so obtained represents the volume of decinormal sodium hydroxid neutralized by the soluble fat acids of the fat, plus that corresponding to the excess of the standard acid used, viz., one cubic centimeter. The number is therefore to be diminished by five, corresponding to the excess of one cubic centimeter of half normal acid. This corrected volume multiplied by 0.0088 gives the weight of soluble acids as butyric acid in the amount of fat saponified.
Insoluble Acids.—The flask containing the cake of insoluble fat acids from the above determination and the paper through which the soluble fat acids have been filtered are allowed to drain and dry for twelve hours, when the cake, together with as much of the fat acids as can be removed from the filter paper, is transferred to a weighed evaporating dish. The funnel, with the filter, is then placed in an erlenmeyer and the paper thoroughly washed with absolute alcohol. The flask is rinsed with the washings from the filter paper, then with pure alcohol, and the rinsings transferred to the evaporating dish. The dish is placed on the steam-bath until the alcohol is evaporated, dried for two hours at 100°, cooled in a desiccator and weighed. It is again placed in the air-bath for two hours, cooled as before and weighed. If there be any considerable decrease in weight, reheat two hours and weigh again. The final weighing gives the weight of insoluble fat acids in the sample, from which the percentage is easily calculated.
The quantity of non-volatile and insoluble acids in common glycerids is from ninety-five to ninety-seven parts in 100. The glycerids yield almost the same proportion of fat acids and glycerol when the acids are insoluble and have high molecular weights. When the acids are soluble and the molecular weight low the proportion of acids decreases and that of glycerol increases.
In the following table will be found the data secured by quantitive [Pg 392] saponification and separation of soluble and insoluble acids found in the more common glycerids:[322]
| Molecular weight of | Yield per 100 parts of glycerid. |
||||
|---|---|---|---|---|---|
| Glycerid. | Fat acid. | Glycerid. | Fat acid. | Fat acid. | Glycerol. |
| Stearin | Stearic | 890 | 284 | 95.73 | 10.34 |
| Olein | Oleic | 884 | 282 | 95.70 | 10.41 |
| Palmitin | Palmitic | 806 | 256 | 95.28 | 11.42 |
| Myristin | Myristic | 722 | 228 | 94.47 | 12.74 |
| Laurin | Lauric | 638 | 200 | 94.95 | 14.42 |
| Caprin | Capric | 594 | 172 | 93.14 | 15.48 |
| Caproin | Caproic | 386 | 116 | 90.16 | 23.83 |
| Butyrin | Butyric | 302 | 88 | 87.41 | 30.46 |
The general expression for the saponification of a neutral fat is C₃H₅O₃.R₃ + 3H₂O = 3R.OH + C₃H₈O₃, in which R represents the acid radicle. It is evident from this that the yield of more than 100 parts of fat acids and glycerol given by glycerids is due to the absorption of water during the reaction.
352. Formulas for General Calculations.—For calculating the theoretical yields of fat acids and glycerol, the following general formulas may be used:
M grams of a fat acid require 56100 milligrams of potassium hydroxid for complete neutralization while F grams corresponding to 100 grams of fat are saturated by 100 × A milligrams of the alkali.
Then M : 56100 = F : 100A.
| Whence F = | AM | (1). |
| 561 |
Likewise since M grams of fat acid require the quantity of potassium hydroxid mentioned above we have: [Pg 393]
1 : K = M : 56100,
| Whence M = | 56100 | (2). |
| K |
Substituting this value of M in (1) we have
| F = | A × 56100 | = | 100A | (3). |
| 561 × K | 561 × K |
It is evident that it is not necessary to calculate the acid value (A) of the sample and the saponification value (K) of the free fat acids, the ratio A/K alone being required. It will be sufficient therefore to substitute for A and K the number of cubic centimeters of alkali solutions required for one gram of the fat and one gram of the fat acids, respectively. If a and b represent these numbers the formula may be written
| F = | 100a | (4); |
| b |
| and N = 100 - F = | 100a | (5). |
| b |
To simplify the determinations, it may be assumed that the free fat acids have the same molecular weight as those still in combination with the glycerol in any given sample. On this assumption, the process may be carried on by determining the acid value A and the saponification value K for the total fat acids. The mean molecular weight M, the percentage of free fat acids F, and the proportion of neutral fat N, may then be calculated from the formulas (2), (3), (4), and (5).
Further, let G = the quantity of glycerol and L that of fat acids obtainable from one gram of neutral fat, that is, ¹/₁₀₀ of H the percentage of total fat acids.
The molecular weight of the neutral fat in each case is 3M + 38. Therefore, 3M + 38 parts of neutral fat yield 3M parts of fat acids and ninety-two parts of glycerol (C₃H₈O₃ = 92).
| Then L = | H | = | 3M | (6); |
| 100 | 3M + 38 |
| and G = | 92 | (7). |
| 3M + 38 |
N per cent of neutral fat yields, therefore, on saponification, [Pg 394] the following theoretical quantities of fat acids F, and glycerol G expressed as parts per hundred.
| F = N × | 3M | (8); |
| 3M + 38 |
| and G = N × | 92 | (9). |
| 3M + 38 |
Formula (9) expresses also the total yield of glycerol from any given sample. For a further discussion of this part of the subject a work of a more technical character may be consulted.[323]
353. Determination of a Free Fat Acid in a Fat.—The principle of the method rests upon the comparative accuracy with which a free fat acid can be titrated with a set alkali solution when phenolphthalien is used as an indicator. Among the many methods of manipulation which the analyst has at his command there is probably none more simple and accurate than that depending on the solution of the sample in alcohol, ether, chloroform, or carbon tetrachlorid. Any acidity of the solvent is determined by separate titration and the proper correction made. Either an aqueous or alcoholic solution of the alkali may be used, preferably the latter. The alkaline solution may be approximately or exactly decinormal, but it is easier to make it approximately so and to determine its real value before each operation by titration against a standard decinormal solution of acid. About ten grams of the sample and fifty cubic centimeters of the solvent will be found convenient quantities.
Example.—Ten grams of rancid olive oil dissolved in alcohol ether require three and eight-tenths cubic centimeters of a solution of alcoholic potash to saturate the free acid present. When titrated with decinormal acid the potash solution is found to contain 25.7 milligrams of potassium hydroxid in each cubic centimeter. The specific gravity of the oil is 0.917 and the weight used therefore 9.17 grams. Then the total quantity of potassium hydroxid required for the neutralization of the acid is 25.7 × 3.8 = 97.7 milligrams.
The acid value A is therefore:
| A = | 3.8 × 25.7 | = 10.6 |
| 9.17 |
[Pg 395] It is customary to regard free acid as oleic, molecular weight 282. On this assumption the percentage of free acids in the above case is found by the formula
| A (per cent) = | 3.8 × 25.7 × 282 | = 5.35 |
| 561 × 9.17 |
354. Identification of Oils and Fats.—Properly, the methods of identifying and isolating the different oils and fats should be looked for in works on food adulteration. There are, however, many characteristics of these glycerids which can be advantageously discussed in a work of this kind. Many cases arise in which the analyst is called upon to determine the nature of a fat and discover whether it be admixed with other glycerids. It is important often to know in a given case whether an oil be of animal or vegetable origin. Many of the methods of analysis already described are found useful in such discriminations. For instance, a large amount of soluble or volatile acids in the sample under examination, would indicate the presence of a fat derived from milk while the form of the crystals in a solid fat would give a clue to whether it were the product of the ox or the swine. In the succeeding paragraphs will be briefly outlined some of the more important additional methods of determining the nature and origin of fats and oils of which the history is unknown.
The data obtained by means of the methods which have been described, both physical and chemical, are all useful in judging the character and nature of a glycerid of unknown origin. The colorations produced by oxidizing agents, in the manner already set forth will be found useful, especially when joined to those obtained with cottonseed and sesame oils yet to be described. For instance, the red coloration produced by nitric acid of 1.37 specific gravity is regarded by some authorities as characteristic of cottonseed oil as well as the reduction by it of silver nitrate. The coloration tests with silver nitrate (paragraph 320) and with phosphomolydic acid (paragraph 318) are also helpful in classifying oils in respect of their animal or vegetable origin. The careful consideration of these tests, together with a study of the numbers obtained by treating the samples with iodin, [Pg 396] and the heat of bromination and sulfuric saponification, is commended to all who are interested in classifying oils. In addition to these reactions a few specific tests are added for more detailed work.
355. Consistence.—It has already been said that oils are mostly of vegetable origin and the solid fats of animal derivation. In the animal economy it would be a source of disturbance to have in the tissues a large body of fat which would remain in a liquid state at the normal temperature of the body. Nearly all the animal fats are found to have a higher melting point than the body containing them. An exception is found in the case of butter fat, but it should be remembered that this fat is an excretion and not intended for tissue building until it has undergone subsequent digestion. Fish oils are another notable exception to the rule, but in this case these oils can hardly be regarded as true glycerids in the ordinary sense of that term.
In general, it may be said that a sample of a glycerid, which in its natural state remains liquid at usual room temperatures, is probably an oil of vegetable origin. Fish oils have also an odor and taste which prevent them from being confounded with vegetable oils. In oils which are manufactured from animal glycerids such as lard oil, the discrimination is more difficult but peculiarities of taste and color are generally perceptible.
356. Nature of the Fat Acid.—When it is not possible to discriminate between samples by the sensible physical properties just described, much light can be thrown on their origin by the determination of their other physical properties, such as specific gravity, refractive index, melting point, etc., in the manner already fully described. Further light may be furnished by saponification and separation of the fat acids. The relative quantities of oleic, stearic, palmitic, and other acids will help to a correct judgment in respect of the nature of the sample. The vegetable oils and lard oils, for instance, consist chiefly of olein; lard and tallow contain a large proportion of stearin; palm oil and butter fat contain considerable [Pg 397] portions of palmitin, and the latter is distinguished moreover by the presence of soluble and volatile acids combined as butyrin and its associated glycerids.
Oleic acid can be rather readily separated from stearic and palmitic by reason of the solubility of its lead salts in ether. One method of accomplishing this separation has already been described (paragraph 339).
357. Separation with Lime.—A quicker, though perhaps not as accurate a separation of the oleic from the palmitic and stearic acids, is accomplished by means of lime according to the method developed by Bondzyuski and Rufi.[324] This process is used chiefly, however, to separate the free fat acids (palmitic, stearic) from the neutral fat and the free oleic acid. It probably has no point of superiority over the lead process.
358. Separation of the Glycerids.—The fact that olein is liquid at temperatures allowing palmitin and stearin to remain solid, permits of a rough separation of these two classes of bodies by mechanical means. The mixed fats are first melted and allowed to cool very slowly. In these conditions the stearin and palmitin separate from the olein in a crystalline form and the olein is removed by pressure through bags. In this way lard is separated into lard oil, consisting chiefly of olein, and lard stearin, consisting largely of stearin. Beef (caul) fat is in a similar manner separated into a liquid (oleo-oil) and a solid (oleo-stearin) portion. It is evident that these separations are only approximate, but by repeated fractionations a moderately pure olein or stearin may be obtained.
359. Separation as Lead Salts.—Muter’s process, with a special piece of apparatus, has already been described (339). For general analytical work the special tube may be omitted. In a mixture of insoluble free fat acids all are precipitated by lead acetate, and the resulting soap may be extracted with ether, either with successive shakings or in a continuous extraction apparatus. In this latter case a little of the lead stearate or palmitate may pass into solution in the hot ether and afterwards separate on cooling. When the operation is conducted on from two to three grams of the dry mixed acids, the percentage proportions of the soluble and insoluble acids (in ether) [Pg 398] can be determined. The lead salt which passes into solution can be decomposed and the oleic acid removed, dried and weighed. Dilute hydrochloric acid is a suitable reagent for decomposing the lead soap. The difference between the weight of the oleic acid and that of the mixed acids before conversion into lead soap furnishes the basis for the calculation. For further details in respect of the fat acids the reader may consult special analytical works.[325]
360. Separation of Arachidic Acid.—Peanut oil is easily distinguished from other vegetable glycerids by the presence of arachidic acid.
The method used in this laboratory for separating arachidic acid is a modification of the usual methods based on the process as carried out by Milliau.[326] About twenty grams of the oil are saponified with alcoholic soda, using twenty cubic centimeters of 36° baumé soda solution diluted with 100 cubic centimeters of ninety per cent alcohol. When the saponification is complete, the soda is converted into the lead soap by treatment with a slight excess of a saturated alcoholic solution of lead acetate. Good results are also obtained by using dilute alcohol, viz., fifty per cent, instead of ninety per cent, in preparing the lead acetate solution.
While still warm the supernatant liquid is decanted, the precipitate washed by decantation with warm ninety per cent alcohol and triturated with ether in a mortar four times, decanting the ethereal solution in each instance. By this treatment all of the lead oleate and hypogaeate are removed and are found in the ethereal solution, from which they can be recovered and the acids set free by hydrochloric acid and determined in the usual way.
The residue is transferred to a large dish containing two or three liters of pure water and decomposed by the addition of about fifty cubic centimeters of strong hydrochloric acid. The lead chlorid formed is soluble in the large quantity of water present, which should be warm enough to keep the free acids in a liquid state in which form they float as a clear oily liquid on the surface. The free acids are decanted and washed with warm water to remove the last traces of lead [Pg 399] chlorid and hydrochloric acid. The last traces of water are removed by drying in a thin layer in vacuo. Practically all of the acids, originally present in the sample except oleic and hypogaeic, are thus obtained in a free state and their weight is determined.
The arachidic acid may be separated almost quantitively by dissolving the mixed acids in forty cubic centimeters of ninety per cent alcohol, adding a drop of hydrochloric acid, cooling to 16° and allowing to stand until the arachidic acid has crystallized. The crystals are purified by washing twice with twenty cubic centimeters of ninety per cent and three times with the same quantity of seventy per cent alcohol. The residual impure arachidic acid is dissolved in boiling absolute alcohol, poured through a filter and washed with pure hot alcohol. The filtrate is evaporated to dryness and heated to 100° until a constant weight is obtained. From the above data, the percentages of oleic, hypogaeic, arachidic and other acids in the sample examined are calculated.
In the above process, owing to the pasty state of the lead soaps, the trituration in a mortar with ether is found troublesome. The extraction of the lead oleate and hypogaeate is facilitated by throwing the pasty ethereal mass on a filter and washing it thoroughly with successive portions of about fifty cubic centimeters of ether. By this variation, it was found by Krug in this laboratory, that less ether was required and a more complete removal of the lead oleate effected. The solution of the lead oleate is completed by about half a dozen washings with ether as above described. The extraction may also be secured by placing the lead soaps in a large extracting apparatus and proceeding as directed in paragraph 40. The residue is washed from the filter paper into a large porcelain dish and decomposed as already described with hydrochloric acid. After the separation is complete, the mixture is cooled until the acids are solid. The solid acids are then transferred to a smaller dish, freed of water and dissolved in ether. The ethereal solution is washed with water to remove any traces of lead salt or of hydrochloric acid. After the removal of the ether, the arachidic acid is separated as has already been described. [Pg 400]
The melting point of pure arachidic acid varies from 73° to 75°.
361. Detection of Arachis (Peanut) Oil.—Kreis has modified the usual process of Renard for the detection of arachis oil, by precipitating the solution of the fat acid with an alcoholic instead of an aqueous solution of lead acetate, in a manner quite similar to that described above.[327] The fat acids are obtained in the usual manner, washed with hot water and the acids from twenty grams of the oil dissolved in 100 cubic centimeters of ninety per cent alcohol. The solution is cooled in ice-water and the fat acids precipitated by the addition of fifteen grams of lead acetate dissolved in 150 cubic centimeters of ninety per cent alcohol. The precipitate, after standing for two hours, is separated by filtration through cotton wool and is extracted for six hours with ether. The residue is boiled with 250 cubic centimeters of five per cent hydrochloric acid until the fat acids appear as a clear oily layer upon the surface. The acids thus obtained are washed with hot water to remove lead chlorid, dried by pressing between blotting paper, dissolved in 100 cubic centimeters of ninety per cent alcohol, cooled to 15° and allowed to stand for several hours, after which time any arachidic acid present is separated by crystallization and identified in the usual manner.
When it is not important to obtain all of the acid present, the process may be simplified in the following manner:
The fat acids obtained from twenty grams of oil are dissolved in 300 cubic centimeters of ether and treated at the temperature of ice-water with a quantity of the alcoholic lead acetate solution mentioned above. Lead oleate remains in solution and the precipitate which forms after a few hours consists almost wholly of the lead salts of the solid fat acids. The precipitate is collected, washed with ether and identified in the usual manner.
362. Cottonseed Oil, Bechi’s Test.—Crude, fresh cottonseed oil, when not too highly colored, and generally the refined article, may be distinguished from other oils by the property of reducing silver salts [Pg 401] in certain conditions. The reaction was first noticed by Bechi and has been the subject of extensive discussions.[328]
The process as proposed by Bechi has been modified in many ways but apparently without improving it. It is conducted as follows: One gram of silver nitrate is dissolved in 200 cubic centimeters of ninety-eight per cent alcohol and forty cubic centimeters of ether and one drop of nitric acid added to the mixture. Ten cubic centimeters of the oil are shaken in a test tube with one cubic centimeter of this reagent, and then with ten cubic centimeters of a mixture containing 100 cubic centimeters of amyl alcohol and ten of colza oil. The mixture is divided into two portions, one of which is put aside for future comparison and the other plunged into boiling water for fifteen minutes. A deep brown or black color, due to the reduction of silver, reveals the presence of cottonseed oil.
In this laboratory the heating is accomplished in a small porcelain dish on which is often deposited a brilliant mirror of metallic silver. The white color of the porcelain also serves as a background for the observation of the coloration produced. In most instances a green color has been noticed after the reduction of the silver is practically complete. Unless cottonseed oil has been boiled or refined in some unusual way, the test, as applied above, is rarely negative. The reduction of the silver is doubtless due to some aldehydic principle, present in extremely minute quantities, and which may be removed by some methods of technical treatment. The silver nitrate test therefore is reliable when the reduction takes place, but the absence of a distinct reaction may not in all cases prove the absence of cottonseed oil.
363. Milliau’s Process.—Milliau has proposed the application of the silver salt directly to the free fat acids of the oil instead of to the oil itself.[329] About fifteen cubic centimeters of the oil are saponified with alcoholic potash in the usual manner, 150 cubic centimeters of water added to the dish and the mixture boiled until the alcohol is evaporated. The fat acids are freed by the addition of decinormal sulfuric acid and as they rise to the surface in a pasty condition are removed with a spoon. The free acids are washed with distilled water. [Pg 402] The water is drained off and the free acids dissolved in fifteen cubic centimeters of ninety-two per cent alcohol and two cubic centimeters of a three per cent solution of silver nitrate. The test tube containing the mixture is well shaken and placed in a water-bath, out of contact with light, and left until about one-third of the alcohol is evaporated. Ten cubic centimeters of water are added, the heating continued for a few minutes and the color of the supernatant fat acids observed. The presence of cottonseed oil is revealed by the production of a lustrous precipitate which colors the fat acids black. In some cases the process of Milliau gives better results than the original method of Bechi, but this is not always the case. It does away with the use of amyl alcohol and colza oil, but its manipulation is more difficult. In all doubtful cases the analyst should apply both methods.
364. Detection of Sesame Oil.—Milliau has pointed out a characteristic reaction of this oil which may be used with advantage in cases of doubtful identity.[330] The identification is based on the fact that the free acids of sesame oil, or some concomitant thereof, give a rose-red color when brought in contact with a solution of sugar in hydrochloric acid.
The analytical process is conducted as follows: About fifteen grams of the oil are saponified with alcoholic soda and when the reaction is complete treated with 200 cubic centimeters of hot water and boiled until the alcohol is removed. The fat acids are set free with decinormal sulfuric acid and removed with a spoon as they rise to the surface in a pasty state, in which condition they are washed by shaking with water in a large test tube. When washed, the acids are placed in an oven at 105° until the greater part of the water is evaporated and the acids begin to become fluid. At this point they are treated with half their volume of hydrochloric acid saturated with finely ground sugar. On shaking the mixture, a rose color is developed which is characteristic of the sesame oil. Other oils give either no coloration or at most a yellow tint.
365. The Sulfur Chlorid Reaction.—Some vegetable oils, when treated with sulfur chlorid, give a hard product similar to elaidin, while lard does not. This reaction is therefore helpful in [Pg 403] discriminating between some vegetable and animal glycerids. The process which is described by Warren has been used with some satisfaction in this laboratory.[331]
Five grams of the oil or fat are placed in a tared porcelain dish and treated with two cubic centimeters of carbon bisulfid and the same quantity of sulfur chlorid. The dish is placed on a steam-bath and its contents stirred until the reaction is well under way. The heating is continued until all volatile products are evaporated, the hard mass being well rubbed up to facilitate the escape of imprisoned vapors. The powdered or pasty mass is transferred to a filter and washed with carbon bisulfid to remove all unaltered oil. The washing with carbon bisulfid is hastened by pressure and about 200 cubic centimeters of the solvent should be used. After drying, the weight of insoluble matter is obtained and deducted from the total weight of the sample used.
The color and tenacity of the hard, insoluble portion are characteristic. The quantitive part of the operation appears to have but little value, but applied qualitively in this laboratory it produces hard, leathery masses with cotton, olive and peanut oils, and but little change in lard and beef fats. Qualitively applied, the process is conducted as described above but without making the weighings. In this instance it is as easy of application as the process of Bechi and is deserving of greater attention than has been given it by analysts.
In the combination which takes place between the sulfur and the fat it is probable that only addition products are formed, since the quantity of alkali required for saponification is not diminished by previously treating the fat with sulfur chlorid.[332] The reactions which take place are probably well represented by the following equations, in which oleic acid is treated with sulfur chlorid:
C₁₈H₃₄O₂ + S = C₁₈H₃₄S.O₂.
C₁₈H₃₄S.O₂ + NaOH = C₁₈H₃₄SO₂Na + H₂O.
366. Detection of Cholesterin and Phytosterin in Glycerids.—Cholesterin is often found in animal glycerids and a corresponding body, phytosterin, is sometimes found in oils of a [Pg 404] vegetable origin.[333] When one of these two bodies is present it may be useful in distinguishing between animal and vegetable glycerids. They are detected as follows: Fifty grams of the glycerids in each case are saponified with alcoholic alkali, preferably potash, in order to have a soft soap. After saponification is complete, the alcohol is evaporated and the residual soap dissolved in two liters of water. The mixture is shaken with ether and the ethereal solution evaporated to a small bulk. The residue, which may contain a small quantity of unsaponified fat, is again treated with alcoholic potash and subjected a second time to the action of ether, as indicated above, with the addition of a few drops of water and of alcohol if the emulsion separate slowly. The ethereal extract finally secured is allowed to evaporate slowly and the cholesterin (phytosterin) is obtained in a crystalline form. The melting point of the cholesterin crystals is 146° and that of the phytosterin 132°.
Cholesterin crystallizes in thin rhombic tables while phytosterin separates in stellar aggregates or in bundles of long needles.
When dissolved in chloroform the two products show different color reactions with sulfuric acid, cholesterin giving a cherry and phytosterin a blue-red tint. In a mixture of animal and vegetable glycerids the two products are obtained together and the melting point of the mixture may afford some idea of the relative quantities of each present. It is evident, however, that no reliable judgment can be formed from these data of the relative proportions of the two kinds of glycerids in the original sample.
367. Cholesterin and Paraffin in Ether Extracts.—In ethereal extracts of some bodies, especially of flowers of the chrysanthemum, paraffin is found combined with cholesterin. The two bodies may be separated as follows:[334]
The ether extract is treated with aqueous then with alcoholic potash several times; the residue soluble in ether is a solid body melting at from 70° to 100°.
If the ethereal solution be cooled in a mixture of snow and salt, a crystalline deposit is formed. This substance, purified by repeated [Pg 405] precipitations, is obtained colorless in fine crystalline scales melting at 64°. It is very soluble in ether, benzene and chloroform, almost insoluble in cold alcohol, and somewhat soluble in hot.
Its percentage composition is:
| Per cent. | |
| Carbon | 85.00 |
| Hydrogen | 14.95 |
It is therefore a paraffin.
The ethereal solution, freed by the above process from paraffin, leaves on evaporation a crystalline mass which is cholesterin, retaining still a small quantity of fat matters. In treating the crystals with alcoholic potash these fat bodies are saponified and the residue is taken up with ether. The cholesterin is obtained in fine needles melting at from 170° to 176°. It presents all the reactions of cholesterin, especially the characteristic reaction with chloroform and sulfuric acid.
368. Absorption of Oxygen.—Among oils a distinction is made between those which oxidize readily and those which are of a more stable composition. Linseed oil, for instance, in presence of certain metallic oxids, absorbs oxygen readily and is a type of the drying oils, while olive oil represents the opposite type.
The method of determining the quantity of oxygen absorbed is due to Livache and is carried out as follows:[335]
Precipitated metallic lead (by zinc) is mixed in a flat dish, with the oil to be tested, in the proportions of one gram of lead to three-quarters of a gram of oil, and exposed to the air and light of the workroom. The dish is weighed from time to time until there is no longer any increase in weight.
Instead of lead, finely divided copper has been used by Krug in this laboratory, but the percentage of absorption of oxygen is not so high with copper as with lead. Krug found the quantities of oxygen absorbed, after nine days, by the samples treated with copper and lead respectively to be the following: [Pg 406]
| Copper, per cent oxygen absorbed. |
Lead, per cent oxygen absorbed. |
|
| Olive oil | 1.69 | 2.03 |
| Cottonseed oil | 4.25 | 5.30 |
| Peanut oil | 2.74 | 3.87 |
| Linseed oil | 5.55 | 7.32 |
Livache found that linseed oil absorbed about twice as much oxygen as indicated by the data just given.
369. Elaidin Reactions.—In discriminating between oils and fats having a preponderance of olein and others with a smaller proportion of that glycerid, the conversion of the olein into its isomer elaidin is of diagnostic value. The following will be found a convenient method of applying this test:[336]
About ten cubic centimeters of the oil are placed in a test tube together with half that quantity of nitric acid and one gram of mercury. The mixture is shaken until the mercury dissolves when the mass is allowed to remain at rest for twenty minutes. At the end of this time it is again shaken and placed aside. In from one to three hours the reaction is complete. Olive, peanut and lard oils give very hard elaidins. The depth to which a plunger of given weight and dimensions sinks into an elaidin mixture at a given temperature, has been used as a measure of the percentage of olein contained in the sample of oil, but it is evident that such a determination is only roughly approximate. Copper may be used instead of mercury for the generation of the oxids of nitrogen, but it is not so effective. The vapors of nitric oxids may also be conducted directly into the oil from a convenient generator. The reaction may also be accomplished by shaking the oil with nitric acid and adding, a drop at a time, a solution of potassium nitrite.
[229] Benedikt and Lewkowitsch; Oils, Fats, Waxes, p. 1.
[230] Op. cit. supra, p. 46.
[231] Archiv für Physiologie, 1895, Band 61, S. 341: Chemiker-Zeitung Repertorium, Band 16, S. 338.
[232] Vid. op. cit. 1, p. 63.
[233] Bulletin No. 46, Division of Chemistry, U. S. Department of Agriculture, p. 25.
[234] Journal of the Society of Chemical Industry, 1886, p. 508.
[235] Bulletin No. 13, Division of Chemistry, U. S. Department of Agriculture, p. 423.
[236] Vid. op. cit. supra, p. 435.
[237] Vid. op. cit. supra, p. 437.
[238] Vid. op. et loc. cit. supra.
[239] Benedikt and Lewkowitsch; Oils, Fats, and Waxes, pp. 96 et seq.: Zune; Analyse des Beurres, pp. 26 et seq.
[240] Journal of the Society of Chemical Industry, 1885, p. 535.
[241] Vid. op. cit. 1, p. 97.
[242] Vid. op. cit. 7, p. 443.
[243] Vid. op. cit. 1, pp. 97 and 98.
[244] Butter, its Analysis and Adulterations, p. 24.
[245] Bulletin No. 46, Division of Chemistry, U. S. Department of Agriculture, p. 34.
[246] Vid. op. cit. 7, p. 447.
[247] Analyse des Beurres, pp. 33 et 63: Zeitschrift für Instrumentenkunde, 1887, Ss. 16, 55, 392, 444: Zeitschrift für physikalische Chemie, Band 18, S. 294. (Ou. pp. 328-9 and 334 read Amagat for Armagat.)
[248] Zeitschrift für physikalische Chemie, Band 18, S. 294.
[249] American Chemical Journal, Vol. 10, p. 392.
[250] Vid. op. cit. 7, pp. 473 et seq.
[251] Jean; Chimie Analytique des Matiéres Grasses, p. 26.
[252] Vid. op. cit. supra, p. 31.
[253] The Analyst, Vol. 20, p. 135.
[254] Schlussbericht über die Butteruntersuchungsfrage, Milchwirthschaftlicher Verein, Korrespondenzblatt, No. 39, 1891, S. 15.
[255] Vid. op. cit. 7, p. 75.
[256] Journal of the American Chemical Society, Vol. 15, p. 173.
[257] Communicated by Krug to author.
[258] Vid. op. cit. 7, pp. 449 et seq.
[259] Vid. op. cit. 28, Vol. 18, p. 189.
[260] Vid. op. cit. 7, Plates 32 and 35.
[261] Vid. op. cit. supra, p. 452.
[262] Vid. op. cit. supra., p. 93.
[263] Vogel; Practische Spectralanalyse, S. 279: Zune; Analyse des Beurres, Tome 2, p. 48: Benedikt and Lewkowitsch; Oils, Fats, Waxes, p. 83.
[264] Bulletin de l’Association Belge des Chimistes, Tome 9, p. 145.
[265] Journal of the Chemical Society, Abstracts, Vol. 46, p. 1078: Dingler’s Polytechnisches Journal, Band 252, S. 296.
[266] The Analyst, July 1894, p. 152.
[267] Rapport sur les Procédé pour reconnâitre les Falsifications des Huiles d’Olive, p. 37.
[268] Vid. op. cit. 7, p. 251.
[269] Taylor; Annual Report U. S. Department of Agriculture, 1877, p. 622: Milliau; Journal of the American Chemical Society, Vol. 15, p. 153.
[270] Gantter; Zeitschrift für analytische Chemie, 1893, Band 32, S. 303.
[271] Welmans; Journal of the Society of Chemical Industry, 1892, p. 548.
[272] Vid. op. cit. 1, p. 254.
[273] Pharmaceutische Zeitung, 1891, p. 798: The Analyst, Vol. 17, p. 59.
[274] Comptes rendus, Tome 112, p. 105.
[275] Pearmain and Moor; The Analyst, Vol. 20, p. 174.
[276] Pharmaceutische Zeitschrift für Russland, 1888, S. 721: American Journal of Pharmacy, 1889, p. 23.
[277] Vid. op. cit. 7, p. 502.
[278] Muir; Elements of Thermal Chemistry, p. 25 et seq.
[279] Comptes rendus, Tome 35 (1852), p. 572.
[280] Allen; Commercial Organic Analysis, Vol. 2, p. 56.
[281] Vid. op. cit. 1, p. 235; et op. cit. 23, p. 217.
[282] Vid. op. cit. 7, p. 44.
[283] Vid. op. cit. supra, p. 445: Proceedings American Public Health Association, Vol. 10.
[284] Vid. op. cit. 23, p. 61.
[285] Journal of the Society of Chemical Industry, 1891, p. 234.
[286] Vid. op. cit. 1, p. 240.
[287] The Analyst, Vol. 22, p. 58.
[288] Vid. op. cit. supra, Vol. 20, p. 146.
[289] Journal of the American Chemical Society, Vol. 17, p. 378.
[290] Dingler’s Polytechnisches Journal, 1884, Ss. 253-281: Journal of the Society of Chemical Industry, 1884, p. 641.
[291] Bulletin No. 46, Division of Chemistry, U. S. Department of Agriculture, p. 32.
[292] Liebermann; Berichte der deutschen chemischen Gessellschaft, Band 24, S. 4117.
[293] Vid. op. cit. 1, p. 136.
[294] Vid. op. cit. 57, 1895, pp. 130 and 1030.
[295] Zeitschrift für analytische Chemie, Band 32, Ss. 181 et seq.
[296] Vid. op. cit. 61, Vol. 16, p. 372.
[297] Zeitschrift für angewandte Chemie, 1895, S. 254.
[298] Chemiker-Zeitung, Band 19, Ss. 1786 and 1831.
[299] Vid. op. cit. 61, Vol. 16, p. 277.
[300] Pharmaceutical Journal, Sept. 25, 1880.
[301] Vid. op. cit. 59, Vol. 20, p. 50.
[302] Williams; vid. op. cit. supra, Vol. 20, p. 277.
[303] Vid. op. cit. 59, 1889, p. 61.
[304] Vid. op. cit. 61, Vol. 15, p. 110.
[305] Zeitschrift für physiologische Chemie, Band 14, S. 599; Band 12, S. 321; Band 16, S. 152.
[306] Vid. op. cit. 1, p. 60.
[307] Vid. op. cit. supra, p. 557.
[308] Vid. op. cit. 7, p. 459; vid. op. cit. 63, p. 27.
[309] Vid. op. cit. 69, 1895, S. 721.
[310] Vid. op. cit. 67, Band 18, S. 199: vid. op. cit. 7, pp. 58-461: vid. op. cit. 63, p. 30.
[311] Vid. op. cit. 52, p. 40.
[312] Vid. op. cit. 1, p. 119.
[313] Vid. op. cit. supra, p. 127.
[314] Monatshefte für Chemie und verwandte Theile anderer Wissenschaften, Band 8, S. 40.
[315] Vid. op. cit. 57, 1890, p. 846.
[316] Reichert; vid. op. cit. 67, Band 18, S. 68.
[317] Meissl; vid. op. cit. 62, Band 233, S. 229.
[318] Vid. op. cit. 1, p. 121.
[319] Vid. op. cit. 63, p. 28.
[320] Vid. op. cit. 67, Band 16, S. 145; Band 18, S. 68: vid. op. cit. 7, p. 53: vid. op. cit. 59, 1877, p. 147.
[321] Vid. op. cit. 57, 1888, pp. 526 and 697: American Chemical Journal, Vol. 10, p. 326: vid. op. cit. 1, pp. 123-127.
[322] Vid. op. cit. 1, p. 143.
[323] Vid. op. ch. 7, p. 143.
[324] Vid. op. cit. 67, 1890, S. 4.
[325] Allen; Commercial Organic Analysis, Vol. 2, pp. 224-236.
[326] Analyse Chimique des Matiéres Grasses, p. 13.
[327] Chemiker-Zeitung, Band 19, S. 451.
[328] Annali del Laboratorio Chimico, 1891-92, p. 197: Bulletin No. 13, Division of Chemistry, U. S. Department of Agriculture, p. 465: Journal of Analytical and Applied Chemistry, Vol. 1, p. 449; Vol. 2, pp. 119 and 275; vid. op. cit. 311.
[329] Rapport presenté a l’Academie Sciences le 20 fevrier, 1883: Analyse des Matiéres Grasses, p. 17: Bulletin No. 13, Division of Chemistry, U. S. Department of Agriculture, p. 446.
[330] Analyse des Matiéres Grasses, p. 15.
[331] Chemical News, 1888, p. 113: Bulletin No. 13, Division of Chemistry, U. S. Department of Agriculture, p. 468.
[332] Vid. op. cit. 69, 1895, S. 535.
[333] Justus Liebig’s Annalen der Chemie, Band 192, S. 178: vid. op. cit. 67, Band 26, S. 575: vid. op. cit. 7, p. 514.
[334] Journal de Pharmacie et de Chimie, 1889, p. 447.
[335] Moniteur Scientifique, Tome 13, p. 263: vid. op. cit. 69, 1884, S. 262.
[336] Vid. op. cit. 7, p. 515.
370. Nature of Nitrogenous Bodies.—The nitrogenous bodies, valuable as foods, belong to the general class of proteids and albuminoids. They are composed chiefly of carbon, hydrogen, oxygen, sulfur and nitrogen. Some of them, as lecithin and nuclein, contain phosphorus instead of sulfur, but these resemble the fats rather than the proteids.
Nitrogenous organic bodies of the class mentioned above are designated by the general name proteids. The term albumin is restricted in a physiological sense to a certain class of proteids. The term albuminoid is often used synonymously, as above, for proteids, but, more strictly speaking, it should be reserved for that class of bodies such as gelatin, mucin, keratin and the like, not really proteids, but, nevertheless, closely resembling them.[337] In chemical composition the proteids are characterized by the relative constancy of their nitrogen content, the mean percentage of this element being about sixteen, but varying in some instances more than two units from that number.
371. Classification of Proteids.—Many classifications of the proteids have been given based on physical, chemical and physiological characteristics. In respect of origin, they are divided into two great classes, viz., vegetable and animal. In respect of their physical and chemical properties the following classification of the proteids may be made.[338]
Albumins.—These are proteids soluble in water and not precipitated from their aqueous solutions by sodium chlorid or magnesium sulfate. They are easily coagulated by heat and are represented by three great classes, viz., egg-, serum-, and lactalbumin.
Egg albumin occurs in the white of egg; serum albumin is found in the serum of the blood. Vegetable albumins have been prepared from wheat, [Pg 411] rye, potatoes, and papaws. (Carica Papaya). These vegetable albumins are coagulated by heat at about 70° and are not precipitated by the salt solutions named above, nor by acetic acid. The myrosin of mustard seeds also resembles vegetable albumin.
Globulins.—These bodies are insoluble in water, soluble in dilute solutions of neutral salts, but precipitated therefrom by saturation with sodium chlorid or magnesium sulfate. They are coagulated by heat. Among others belonging to this group are serum globulin, fibrinogen, myosin, crystalin, and globin.
Serum globulin is found in the serum of blood; cell globulin is found in lymph cells; fibrinogen occurs in the blood plasma; plasmin, in blood plasma; myosin, in dead muscles; vitellin, in the yolk of eggs; crystalin, in the lens of the eye; haemoglobin, in the red pigment of the blood; haemocyanin, in the blood of certain low grade animals.
Vegetable globulins are found in the cereals, leguminous plants, papaws and other vegetables, and are divided into two groups, myosins and paraglobulins. The vegetable myosins coagulate at from 55° to 60° and are precipitated from a saline solution by removing the salt by dialysis. In this form, however, they lose their true nature as globulins, becoming insoluble in weak saline solutions.
The vegetable paraglobulins are coagulated at from 70° to 75°. Vegetable vitellin, which is not included in this classification, can be obtained in a crystalline form and of remarkable purity.[339]
Albuminates.—This name is given to the compounds of the proteids with metallic oxids or bases, and also to acid and alkali albumins. They are insoluble in water or dilute neutral salts, but easily soluble in strong acids or alkalies. Casein is a type of this group.
Acid albumin is made from egg albumin by treatment with hydrochloric acid; alkali albumin is formed in egg albumin by the action of a dilute alkali; trinitroalbumin is formed from dry albumin by treatment with nitric acid; casein or caseinogen is the chief proteid in milk.
The chief vegetable albuminates are legumin and conglutin. Legumin is a vegetable casein and occurs chiefly in peas, beans and other leguminous [Pg 412] seeds. It is prepared by extracting the meal of the seeds mentioned with dilute alkali, filtering the extract, precipitating with acetic acid, washing the precipitate with alcohol, and drying over sulfuric acid. Treated with sulfuric acid it yields leucin, tyrosin and glutamic and aspartic acids. Conglutin is prepared in a similar manner from almonds.
It is probable that these bodies do not exist as such in the fresh seeds in question but are produced therein from the other proteids by the alkali used in extraction. A further description of vegetable proteids will be found in the special paragraphs devoted to the study of these bodies in the principal cereals.
Proteoses.—This name is applied to proteids which are not coagulated by heat, but most of them are precipitated by saturated solutions of neutral salts. They are also precipitated by nitric acid. They are formed from other proteids by the action of proteolytic ferments. The albumoses represent this group.
Protoalbumose is soluble in distilled water and weak saline solutions and is precipitated by mercuric chlorid and copper sulfate.
Heteroalbumose is insoluble in distilled water, but soluble in weak saline solutions, from which it separates when the salts are removed by dialysis. Deuteroalbumose is soluble in distilled water and saline solutions and is not precipitated on saturation with sodium chlorid. It is thrown out by mercuric chlorid but not by copper sulfate.
Vegetable proteoses are known as phytalbumoses, two of which have been found in the juice of the papaw mentioned above. They have also been found in cereals.
Peptones.—These bodies are very soluble in water but are not thrown out by heat, by saturation with neutral salts, nor by nitric acid. They are completely precipitated by tannin and by strong alcohol.
The peptones are the only soluble proteids which are not precipitated by saturation with ammonium sulfate. The principal animal varieties are hemi- and anti-peptones. These forms of proteids do not appear to exist as such in vegetable products but are produced in large quantities by treating other proteids with pepsin or pancreatin. In sprouting plants, there appears to be a widely diffused ferment capable of converting the [Pg 413] proteids of the cotyledons into peptonoid bodies and thus fitting them for entering the tissues of the new plant.
Insoluble Proteids.—This class includes a miscellaneous collection of nitrogenous bodies not belonging to any of the definite groups already mentioned. Fibrin and gluten are types of these insoluble bodies. Fibrin is formed from the fibrinogen of fresh blood and causes coagulation. When washed free of red blood corpuscles it is a white elastic solid. It is insoluble in water and is converted into albumoses and peptones by trypsin and pepsin. It swells up when treated with a very weak one-tenth per cent solution of hydrochloric acid and dissolves to acid albumin when heated therewith.
Gluten is the most important of the insoluble vegetable proteids and forms the chief part of the nitrogenous constituents of wheat. It is readily prepared by washing wheat flour in cold water, as will be described further on. It is probably a composite body formed by the process of extraction from at least two proteid bodies existing in wheat. When dried it forms a horny elastic mass of a yellow-gray color. Gluten is composed of two bodies, one soluble the other insoluble in alcohol. The part insoluble in alcohol has been called vegetable fibrin, and the soluble part is subdivided into two portions, one unicedin or vegetable unicin, and the other glutin (gliadin) or vegetable gelatin. Gluten, according to some authorities, does not properly exist in wheat flour, but is formed therein by the action of water and certain ferments from free existing proteids. A better explanation of the composition of gluten is that of Osborne, which will be given further on.
372. Albuminoids.—In this paragraph the term albuminoids is not employed as synonymous with proteids but as characteristic of a class of bodies nearly resembling them, but, nevertheless, differing from them in many important particulars. Following is an abstract of their classification as given in Watt’s dictionary.[340]
Collagen.—The nitrogenous portions of connective tissues are largely composed of collagen. By boiling water it is converted into gelatin. It may be prepared from tendons as follows: The tendinous [Pg 414] tissues are shredded as finely as possible and extracted with cold water to remove the soluble proteids. Thereafter they are subjected for several days to the action of lime water, which dissolves the cement holding the fibers together. The residual insoluble matter is washed with water, weak acetic acid, and again with water. The residue is chiefly collagen, mixed, however, with some elastin and nuclein. With dilute acids and alkalies collagen swells up after the manner of fibrin. The organic nitrogenous matter of bone consists largely of collagen, which is sometimes called ossein.
Gelatin.—When the white fibers of collagen, obtained as above, are subjected to the action of boiling water or of steam under pressure they dissolve and form gelatin. Isinglass is a gelatin made from the swimming bladder of the sturgeon or other fish. Glue is an impure gelatin obtained from hides and bones. Pure gelatin may be prepared from the commercial article by removing all soluble salts therefrom by treatment with cold water, dissolving in hot water and filtering into ninety per cent alcohol. The gelatin separates in the form of white filaments and these are removed and dried. Gelatin is insoluble in cold but soluble in hot water. It is insoluble in alcohol, ether and chloroform. Its hot aqueous solutions deflect the plane of polarized light to the left. Its gyrodynat varies with temperature and degree of dilution and is also influenced by acids and alkalies. At 30° it is [α]D³⁰° = -130.
Gelatin is not precipitated by acetic acid nor lead acetate solution, in which respect it differs from chondrin.
If boiled for a day, or in a short time if heated to 140° in a sealed tube, gelatin loses its power of setting and is split up into two peptonoid bodies, semi-glutin and hemi-collin. Gelatin is easily digested but cannot take the place of other proteids in nutrition.
Mucin.—This albuminoid, together with globulin, forms the principal part of connective tissue. It is also present in large quantities in mucus and is the chief lubricant of mucous membranes. It is extremely difficult to prepare mucin in a state of purity, and it is [Pg 415] not certain that it has ever been accomplished. It is precipitated but not rendered subsequently insoluble by sodium chlorid, magnesium sulfate and alcohol. When boiled with sulfuric acid it yields leucin and tyrosin and, with caustic soda, pyrocatechin.
Met- and Paralbumin.—Metalbumin is a form of mucin and differs from paralbumin by giving no precipitate when boiled. Both bodies yield reducing sugars when boiled with dilute sulfuric acid.
Nuclein.—The nitrogenous matters which form the nuclei of the ultimate cells are called nuclein. Nuclein resembles mucin in many physical properties but contains phosphorus. It is also, like mucin, resistant to pepsin digestion. The nuclein of eggs and milk probably contains iron. Nuclein is found also in cells of vegetable origin and in yeast and mildew.
Nucleoproteids.—These are bodies which yield both nuclein and albumin when boiled with water or treated with dilute acids or alkalies. Many nucleoproteids have the physical properties of mucus and the sliminess of the bile and of the synovial liquid is due to them. They are the chief nitrogenous constituent of all protoplasm.
Chondrin.—Chondrin is obtained from cartilage by boiling with water. The solutions of chondrin set on cooling in the manner of gelatin. They are precipitated by the same reagents used for throwing out gelatin and mucin. Chondrin is also levorotatory. By some authorities chondrin is regarded as a mixture of gelatin and mucin.
Elastin.—The elastic fibers of connective tissue are composed of this material. It can be prepared from the neck muscles by boiling with ether and alcohol to remove fats and then for a day and a half with water to extract the collagens. The residue is boiled with strong acetic acid and thereafter with strong soda until the fibers begin to smell. It is then treated with weak acetic acid and for a day with dilute hydrochloric acid. The acid is removed by washing with water and the residue is elastin. There is no solvent which acts on elastin without decomposing it. It is digested by both pepsin and trypsin with the formation of peptones. [Pg 416]
Keratin.—This nitrogenous substance is found chiefly in hairs, nails, and horns. It is essentially an alteration proteid product due to peripheral exposure. It is prepared by digesting the fine ground material successively with ether, alcohol, water and dilute acids. The residue is keratin. An imperfect aqueous solution may be secured by heating for a long time under pressure to 200°. It is also dissolved by boiling the materials mentioned above with alkalies, and when the solution thus obtained is treated with water, hydrogen sulfid is evolved, showing that the sulfur of the molecule is loosely combined.
Horn swells up when treated with dilute acetic acid and dissolves in the boiling glacial acid. When treated with hot dilute sulfuric acid it yields aspartic and volatile fat acids, leucin and tyrosin. Keratin, when burning, gives off a characteristic odor as is perceived in burning hair.
Other Albuminoids.—Among the albuminoids of less importance may be mentioned neurokeratin found in the medullary sheath of nerve fibers; chitin occurring in the tissues of certain invertebrates; conchiolin, found in the shells of mussels and snails; spongin, occurring in sponges; fibroin forming silk and spiders webs; and hyalin or hyalogen found in edible birds’ nests.
The nitrogenous bases in flesh which are soluble in cold water, viz., kreatin, kreatinin, carnin, sarkin and xanthin are not classed among the albuminoid bodies, since they have a much higher percentage of nitrogen than is found in true proteid bodies, and are further differentiated from them by the absence of sulfur.
373. Other Forms of Nitrogen.—In addition to the proteids and albuminoids mentioned above, agricultural products may contain nitrogen in the form of ammonia, amid nitrogen and nitric acid. The quantities of nitrogen thus combined are not large but often of sufficient magnitude to demand special study. In general, these bodies belong to transition products, representing stages in the transfer of nitrogen from the simple to complex forms of combination, or the reverse.
For instance, the nitrogen which finally appears in the proteids of a [Pg 417] plant has entered its organism chiefly as nitric acid, and the nitric acid which is found in a vegetable product is therefore a representative of the quantity of unabsorbed nitrogen present in the tissues at the moment when the vital activity of the plant is arrested. In some instances, it is found that the absorption of nitrates by vegetable tissues takes place in far larger quantities than is necessary for their nutrition, and in these cases the excess of nitrates accumulates, sometimes to a remarkable extent. In a case cited in the reports of the Kansas Agricultural Experiment Station, where Indian corn was grown on ground which had been used for a hog pen, the quantity of potassium nitrate found in the dried stalks was somewhat remarkable. When one of the stalks was cut in two and tapped lightly upon a table, crystals of potassium nitrate were easily obtained in the form of fine powder. On splitting the cornstalk the crystals in the pith could be seen without the aid of a microscope. On igniting a piece of the dried stalk it burned rapidly with deflagration. The percentage of potassium nitrate in the dried material was 18.8. Cattle eating this fodder were poisoned.[341]
In preserved meat products large quantities of oxidized nitrogen are often found, and these come from the use of potassium nitrate as a preserving and coloring agent. Ammonia is rarely found in vegetable tissues in greater quantities than mere traces, but may often exist in weighable amounts in animal products.
Amid nitrogen is found rather constantly associated with proteid matters in vegetable products. Asparagin and glutamin are instances of amid bodies of frequent occurrence. Betain and cholin are found in cottonseed.
The occurrence of nitrogen, in the form of alkaloids, is of interest to agricultural chemists in this country, chiefly from its presence as nicotin in tobacco and from a toxicological point of view, but in other localities the production of alkaloids, as for instance in opium, tea and coffee, is a staple agricultural industry. The methods of separating and determining these forms of nitrogen will be given further on. This description can evidently not include an extended compilation of the methods of separating and determining alkaloidal bodies, with the exception of those with which the agricultural analyst [Pg 418] will be called upon frequently to deal, viz., nicotin and caffein and nitrogenous bases such as betain and cholin.
374. Nitric Acid.—Any nitric acid or nitrate which an agricultural product may contain may be leached out by treating the fine-ground material with cold water. From vegetable matters this extract is evaporated to a small bulk, filtered, if necessary, and tested for nitric acid by the usual treatment with ferrous sulfate and sulfuric acid. In the case of vegetable substances there will not usually be enough of organic matter to interfere with the delicacy of the reaction, but in animal extracts this may occur. Colored extracts should be decolorized with animal char (bone-black) before they are subjected to examination. It is not well to attempt to remove the organic matters, but, since they are more insoluble in water than the nitrates, the solution containing both may be evaporated to dryness and treated with a quantity of cold water insufficient for complete solution. The nitrates will be found in the solution obtained in a larger proportionate quantity than before.
375. Amid Nitrogen.—One or more atoms of the hydrogen in ammonia may be replaced by acid or basic bodies (alcohol radicles). In the former cases amids, in the latter amins result. In the ratio of displacement there are formed primary, secondary, and tertiary bodies determined by the number of hydrogen atoms replaced. The primary amids are the only ones of these bodies that are of interest in this connection.
The amids are easily decomposed, even on heating with water and the more readily with acids and alkalies, the amido radicle being converted into ammonia. A type of these reactions is given below.
CH₃.CO.NH₂ + H₂O = CH₂.CO.OH + H₃N.
On boiling an amid with hydrochloric acid, the ammonia is procured as chlorid whence it is easily expelled by heating with an alkali. In a body free of ammonia, an amid is easily detected by subjecting the substance containing it to the action of hot hydrochloric acid, filtering, neutralizing the free acid with sodium hydroxid, adding an [Pg 419] excess thereof and distilling into an acid.[342] In case the quantity of ammonia produced is very small it may be detected by the nessler reagent.[343] Amids are soluble in a fresh, well washed preparation of cupric hydrate suspended in water. The hydrate also passes into solution forming a liquid of a deep blue color.
If amids be added to a cold solution of potassium nitrate in sulfuric acid free nitrogen is evolved.
376. Ammoniacal Nitrogen.—This combination of nitrogen may be detected by distilling the sample, or an aqueous extract thereof, with magnesia or barium carbonate. The ammonia is collected in an acid and detected therein by the usual qualitive reactions.
377. Proteid Nitrogen.—There are a few general qualitive reactions for proteid nitrogen and some special ones for distinct forms thereof. Below will be given a few of those reactions which are of most importance to the agricultural analyst:
Conversion into Ammonia.—All proteid matters are converted into ammonia on boiling with strong sulfuric acid in presence of an oxygen carrier. Mercury is the substance usually selected to effect the transfer of the oxygen. Bodies which are found to be free of nitrates, ammonia and amids, are subjected directly to oxidation with sulfuric acid, and the ammonia produced thereby is distilled and detected in the manner already suggested. If nitrogen be present in the form of ammonia, amids and nitrates, the substance may be heated with an acid, hydrochloric or acetic, thrown on a filter, washed with hot dilute acid and the residue tested as above for proteid nitrogen.
Biuret Reaction.—When proteid matter is dissolved in sulfuric acid, the solution, made alkaline with potassium hydroxid and treated with a few drops of a solution of copper sulfate, gives a violet coloration. This is commonly known as the biuret reaction, because the substance C₂H₆N₃O₂, biuret, left on heating urea to 160° gives the coloration noted in the conditions mentioned.
It has been found by Bigelow, in this laboratory, that if a solution is to be examined containing a very small amount of a proteid or similar body, the copper sulfate solution should not contain more than four [Pg 420] grams of CuSO₄.5H₂O in 100 cubic centimeters of water, and the test should first be made by adding to the solution one or two drops of this copper sulfate solution, and then a strong excess of potassium or sodium hydroxid. The test may be repeated, using from one-half to two cubic centimeters of the copper sulfate solution, according to the amount of proteid present. If too much of the copper sulfate solution be employed its color may conceal that of the reaction.
Heating to the boiling point sometimes makes the violet color more distinct.
If a solid is to be examined it is first suspended in water, and in this state treated in the same manner as a solution. If solution is not complete, the mixture should be filtered when the color produced may be observed in the filtrate.
Proteoses and peptones give a red to red-violet and other proteids a violet to violet-blue coloration.
Xanthoproteic Reaction.—Strong nitric acid produces a yellow coloration of proteid matter, which is intensified on warming. On treating the yellow mixture with ammonia in slight excess the color is changed to an orange or red tint.
378. Qualitive Tests for Albumin.—Albumin is one of the chief proteids and exists in both animal and vegetable substances. It is soluble in cold water and may therefore be separated from many of its nearly related bodies which are insoluble in that menstruum. In aqueous solutions its presence may be determined by the general reactions for proteid matters given above or by the following tests:
Precipitation by Heat.—Albumin is coagulated by heat. Vegetable albumins become solid at about 65° and those of animal origin at a somewhat higher temperature (75°). Some forms of animal albumin, however, as for instance that contained in the serum, coagulate at a lower temperature.
Precipitation by Acids.—Dilute acids also precipitate albumins especially with the aid of heat. Practically all the albumins are thrown out of solution by application of heat in the presence of dilute acids.
Mercuric Salts.—Acid mercuric nitrate and a mixture of mercuric chlorid, potassium iodid and acetic acid completely precipitate all albuminous matters.[344]
[Pg 421] The yellow or red color produced on heating albumin with the mercuric nitrate is known as Million’s reaction.
379. Qualitive Test for Peptones and Albuminates.—When peptones and albuminates are dissolved in an excess of glacial acetic acid and the solution treated with sulfuric acid a violet color is produced and also a faint fluorescence.
Separation of Peptones and Albumoses.—In a solution of peptones and albumoses the latter may be precipitated by saturating the solution with finely powdered zinc or ammonium sulfate.
Action of Phosphotungstic Acid.—All proteid matters in aqueous, alkaline or acid solutions, are precipitated by sodium phosphotungstate in a strongly acid solution. Acetic, phosphoric, or sulfuric acid may be used for producing the required acidity, preference being given to the latter.
Action of Trichloracetic Acid.—In the precipitation of albumin by trichloracetic acid, there is formed a compound of the two bodies which to 100 parts of albumin has 26.8 parts of the trichloracetic acid.
The different albuminoid bodies obtained by precipitation behave in a similar manner. There are formed flocculent precipitates insoluble both in dilute and concentrated acids in the cold and also at a high temperature, with the exception of the hemialbumose compound.[345]
Albumin peptone, however, gives with the acid named in concentrated solution a precipitate easily soluble in an excess of the reagent. In the analysis of cow’s milk but not of human milk, this acid can be used for the estimation of the albuminoid substances. With both kinds of milk it can be used for the estimation of the albumin after the removal of the casein.
After precipitation of the albuminoid bodies, the milk sugar can be estimated by polarizing the filtrate and, volumetrically after removal of the excess of the acid by evaporation. By means of trichloracetic acid it is possible to separate albumin peptone from mucus and mucus peptone. A similar reaction is also produced by dichloracetic acid, but the reaction with this last agent is less delicate than with the other. Neither mucus nor albumin is precipitated by chloracetic acid. [Pg 422]
380. Action of Albumins on Polarized Light.—Many of the albumins and albuminates, when in solution, strongly deflect the plane of polarized light to the left.[346]
The gyrodynats of some of the albumins and albuminates are given below:
| Serum albumin | [α]D = | -57°.3 to -64°.6. |
| Egg albumin | [α]D = | -35°.5 to -38°.1. |
| Serum globulin | [α]D = | -47°.8. |
| Milk albumin | [α]D = | -76°.0 to -91°.0. |
Our knowledge of the gyrodynatic numbers of the proteids and allied bodies is too fragmentary to be of any great help in analytical work. In practice, the rotatory power of these bodies becomes a disturbing force in the determination of milk sugar.[347] A further study of this property of certain proteids may lead to analytical processes for their detection and determination, but no reliable methods for this can now be recorded.
381. Alkaloidal Nitrogen.—Only a general statement can be made here in respect of the detection of alkaloidal nitrogen in vegetable or animal tissues. Alkaloids are not found in healthy animal tissues and the description of methods for isolating and detecting ptomaines is foreign to the purpose of this work. In vegetable tissues the presence of alkaloids may be established by the following methods of examination.
The fine-ground tissues are made to pass a sieve of half millimeter mesh and when suspended in water are acidified with sulfuric. The mixture is then thoroughly extracted by shaking in a separatory funnel with petroleum ether, benzene and chloroform, successively. Some resins, glucosids and a few alkaloidal bodies not important here are extracted by this treatment.
The residue is made distinctly alkaline with ammonia and treated as above with the same solvents. In the solution obtained as last mentioned nearly all the alkaloidal bodies found in plants are contained.
All the alkaloids in a plant may be obtained by digesting the finely divided material with dilute sulfuric acid. The acid solution thus obtained is made nearly neutral with ammonia or magnesia, concentrated [Pg 423] to a sirup, and gums, mucilage, etc. thrown out by adding about three volumes of ninety-five per cent alcohol. The alkaloids are found in the filtrate. The alcohol is evaporated from the filtrate and the residue tested for alkaloids by group reagents.[348] Potassium mercuric iodid and phosphotungstic and molybdic acids are types of these reagents.
The same group reagents may also be applied to the extracts obtained with petroleum ether, benzene and chloroform, in all cases, after the removal of the solvents by evaporation.
382. Total Nitrogen.—Any one of the methods heretofore described for the estimation of total nitrogen in soils or fertilizers is applicable for the same purpose to agricultural products. One among these, however, is so superior in the matter of convenience and certainty, as to make it preferable to any other. The moist combustion of the sample with sulfuric acid with subsequent distillation of the ammonia produced is the process which is to be recommended.[349]
The usual precautions for securing a representative sample should be observed, but no further directions are needed. In all cases hereafter, where the estimation of nitrogen is enjoined, it is understood that the moist combustion process is to be used unless otherwise stated.
383. Estimation of Ammoniacal Nitrogen.—If the distillation of ammonia be accomplished with the aid of magnesia alba or barium carbonate it may be safely conducted on the finely ground materials or, in case of animal bodies, in as fine a state of subdivision as may be conveniently secured. Since the salts of ammonia are easily soluble in water they may be all obtained in aqueous solution, and the distillation of this solution with magnesia gives correct results. Experience has shown that the stronger alkalies, such as sodium and potassium hydroxids, cannot be safely used in the distillation of ammonia from mixtures containing organic nitrogenous materials because [Pg 424] of the tendency of these bodies to decomposition, in the circumstances, yielding a portion of their nitrogen as ammonia. Barium carbonate acts with less vigor on non-ammoniacal nitrogenous matters than magnesia, and in some cases, as pointed out further on, may be substituted therefor with advantage. There is no danger of failing to obtain a part of the ammonia on distillation with magnesia provided the latter does not contain more than a trace of carbonate.[350]
When no easily decomposable organic nitrogenous matters are present, the distillation may be conducted with the stronger alkalies in the manner prescribed.[351] All the necessary details of conducting the distillation are found in the preceding volumes of this work.
384. Estimation of Amid Nitrogen.—In bodies containing no ammonia, or from which the ammonia has been removed by the method described in the preceding paragraph, the nitrogen in the amid bodies is converted into ammonia by boiling for about an hour with five per cent sulfuric or hydrochloric acid. The ammonia thus produced is estimated in the usual manner after distillation over magnesia free of carbonate. The free acid is exactly neutralized with sodium or potassium carbonate before the addition of the magnesia. The results are given in terms of asparagin. The reaction which takes place in the decomposition of the amid body is indicated by the following equation:
| Asparagin. | Sulfuric acid. |
||
| 2C₄H₈N₂O₃ + 2H₂O | + | H₂SO₄ | = |
| Aspartic acid. | Ammonium sulfate. |
||
| 2C₄H₇NO₄ | + | (H₄N)₂SO₄. | |
Half of the nitrogen contained in the amid body is thus obtained as ammonia.
It is advisable to calculate all the amid nitrogen in agricultural products as asparagin.
385. Sachsse’s Method.—A method for the determination of amid bodies by liberation of free nitrogen has been described by Sachsse and Kormann.[352] It is based on the reaction which takes place when amid bodies are brought into contact with nitrites in presence of an acid. The mixture of the reagents by which the gas is set free is accomplished in the [Pg 425] apparatus shown in Fig. 103. The vessel A has a capacity of about fifty cubic centimeters and carries a stopper with three perforations for the arrangement shown.

Fig. 103.—Apparatus
for Amid Nitrogen.

Fig. 104.—Sachsse’s Eudiometer.
About six cubic centimeters of a concentrated aqueous solution of potassium nitrite are placed in A and the lower parts of the tubes a and b are filled with water to a little above e in order to exclude the air therefrom. Dilute sulfuric acid is placed in one of the funnels and an aqueous solution of the amid in the other. The air is displaced from the empty part of A by introducing the sulfuric acid, a little at a time, whereby nitrous acid and nitric oxid are evolved. This operation is continued until all the air has been driven out through c d, the open end of d being kept in the liquid in the dish shown in Fig. 104. The eudiometer in which the evolved nitrogen is measured is shown in Fig. 104, and should have a capacity of about fifty cubic centimeters, and be graduated to fifths. It is filled with the solution of ferrous sulfate contained in B by sucking at g, after which the clamp h is replaced, the cock f closed, and the free end of d placed in the lower end of the eudiometer. The solution of the amid is run slowly into the generator A, Fig. 103, together with small additional quantities of the sulfuric acid when the evolution of gas becomes slow. From time to time h is opened and fresh quantities of the ferrous solution allowed [Pg 426] to flow into the eudiometer. Any trace of the amid remaining in the funnel is washed into A with pure water, with care to avoid the introduction of air. When the liquid in A assumes a permanent blue color the decomposition is complete. The residual gas is driven out of A by filling with water. The tubes d and h, after all the nitric oxid is absorbed, are removed from the eudiometer which is transferred to a cylinder containing water and immersed therein until the two liquid surfaces are at the same level and the volume of the nitrogen observed. After correction for temperature and pressure, the weight of the nitrogen is calculated. Twenty-eight parts by weight of nitrogen correspond to 150 of pure asparagin, 181 of tyrosin and 131 of leucin.[353] This method of procedure is difficult of manipulation and is apt to give results that are too high. It cannot be preferred to the more simple and accurate processes already described.
386. Preparation of Asparagin.—In case the analyst desires to prepare a quantity of asparagin for comparative purposes it may be easily accomplished in the following way: A sufficient quantity of pease or beans is sprouted in a dark place and allowed to grow until the reserve food of the seed is exhausted. The young sprouts are gathered, shredded and subjected to strong pressure. The juice thus obtained is boiled to coagulate the albumin, and thrown on a filter. The filtrate is evaporated to a thin sirup and set aside to allow the asparagin to separate in a crystallized form. If the crystals at first formed are colored they may be dissolved, decolorized with bone-black, and recrystallized. Instead of the above method the young shoots may be shredded, extracted with hot water and the extract treated as above. A larger yield of the asparagin is obtained by the latter process than by the one mentioned above.[354]
387. Detection and Estimation of Asparagin and Glutamin.—Of all the amid bodies asparagin is the most important from an agricultural standpoint, because of its wide distribution in vegetable products.[355] Asparagin is easily obtained from the aqueous extracts of plants by crystallization.[356] In addition to its crystalline characteristics asparagin may be identified by the following tests. Heated with alkalies, including [Pg 427] barium hydroxid, asparagin yields ammonia. Boiled with dilute acids it forms ammonium salts. A warm aqueous solution dissolves freshly prepared copper hydroxid with the production of a deep blue color. Sometimes, on cooling, crystals of the copper compound formed are separated. Asparagin crystallizes with one molecule of water. Glutamin gives essentially the reactions characteristic of asparagin, but crystallizes without water in small white needles. Asparagin is easily detected with the aid of the microscope by placing sections of vegetable tissues containing it in alcohol. After some time microscopic crystals of asparagin are separated. The presence of large quantities of soluble carbohydrates seriously interferes with the separation of asparagin in crystalline form.
For the detection of glutamin the liquid containing it is boiled with dilute hydrochloric acid, by which ammonia and glutamic acid are formed. On the addition of lead acetate to the solution the glutamic acid is thrown out as a lead salt, in which, after its decomposition with hydrogen sulfid, the characteristic properties of glutamic acid can be established.
The above process is chronophagous and also uncertain where the quantity of glutamin is very small and that of other soluble organic matters very large. A much better process, both for the detection of glutamin and asparagin, is the following, based on the property possessed by mercuric nitrate of precipitating amids.
The aqueous extract containing the amid bodies is mixed with lead acetate until all precipitable matters are thrown out and the mixture poured into a filter. To the filtrate is added a moderately acid solution of mercuric nitrate. The precipitate produced is collected on a filter, washed, suspended in water, decomposed with hydrogen sulfid and again filtered. The amid bodies (glutamin, asparagin, etc.) are found in the filtrate and can be detected and estimated by the processes already described. A reaction showing the presence of an amid body is not a positive proof of the presence of asparagin or glutamin, since among other amids, allantoin may be present. This substance is [Pg 428] found in the sprouts of young plants and also in certain cereals, as shown by researches in this laboratory.[357] Allantoin, glutamin, and asparagin, when obtained in solution by the above process, may be secured, by careful evaporation and recrystallization, in well defined crystalline forms. Asparagin gives lustrous, rhombic prisms, easily soluble in hot water, but insoluble in alcohol and ether.
Allantoin is regarded as a diureid of glyoxalic acid and has the composition represented by the formula C₄H₆N₄O₃. It crystallizes in lustrous prisms having practically the same solubility as asparagin.
Glutamin is the amid of amidoglutaric acid. It crystallizes in fine needles. Its structural formula is represented as
387. Cholin and Betain.—Cholin is a nitrogenous base found in both animal and plant tissues. Its name is derived from the circumstance that it was first discovered in the bile. It is found in the brain, yolk of eggs, hops, beets, cottonseed and many other bodies. When united with glycerolphosphoric acid it forms lecithin, a compound of great physiological importance. From a chemical point of view, cholin is oxyethyltrimethyl-ammonium hydroxid,
It is crystallized with difficulty and is deliquescent. Its most important compound, from an analytical point of view, is its platinum salt C₅H₁₄ONCl₂PtCl₄. This salt crystallizes in red-yellow plates and is insoluble in alcohol.
Betain, C₅H₁₁NO₂, is the product of the oxidation of cholin.
In this laboratory the bases are separated from cottonseed and from each other by the process described below.[358]
About five pounds of fine-ground cottonseed cake are extracted with seventy per cent alcohol. The material should not be previously treated with dilute mineral acids because of the danger of converting a part of the cholin into betain. The alcohol is removed from the filtered extract and the residue dissolved in water. The aqueous solution is treated with lead acetate until no further precipitation takes place, thrown on a filter, the lead removed from the filtrate with hydrogen [Pg 429] sulfid and the liquid evaporated to a viscous syrup. The sirup is extracted with alcohol containing one per cent of hydrochloric acid. The solution thus obtained is placed in a deep beaker and the bases precipitated by means of an alcoholic solution of mercuric chlorid. The complete separation of the salts requires at least two weeks.
The double salts of the bases and mercury thus obtained, after freeing from the mother liquor, are recrystallized from a solution in water and from the pure product thus obtained the mercury is removed after solution in water, by hydrogen sulfid. The filtrate, after separating the mercury, contains the bases as chlorids (hydrochlorates). The solution of the chlorids is evaporated slowly in (pene) vacuo to a thick sirup and set over sulfuric acid to facilitate crystallization. The hydrochlorates are obtained in this way colorless and in well-shaped crystalline forms.
In a quantitive determination, a small amount of the fine meal is extracted at once with one per cent hydrochloric acid in seventy per cent alcohol, the salts obtained purified as above and weighed.
The following process serves to determine the relative proportions of cholin and betain in a mixture of the two bases.
A definite weight of the chlorids, prepared as directed above, is extracted by absolute alcohol. This treatment dissolves all the cholin chlorid and a little of the betain salt. The alcoholic solution is evaporated and again extracted with absolute alcohol. This process is repeated three times and at the end the cholin chlorid is obtained free of betain. In a sample of cottonseed cake examined in this laboratory the two bases were found present in the following relative proportions, viz., cholin 17.5 per cent, betain 82.5 per cent. Thus purified the cholin is finally precipitated by platinum chlorid. For a description of the special reaction, by means of which cholin and betain are differentiated, the paper cited above may be consulted.
These bodies have acquired an economic interest on account of their occurrence in cottonseed meal, which is so extensively used as a cattle food. It is evident from the relative proportions in which they occur [Pg 430] that the less nocuous base, betain, is the more abundant. It is possible, however, that the base originally formed is cholin and that betain is a secondary product.
Experience has shown that it is not safe to feed cottonseed meal to very young animals, while moderate rations thereof may be given to full-grown animals without much expectation of deleterious results. In the case of toxic effects it is fair to presume that a meal has been fed in which the cholin is relatively more abundant than the betain.
389. Lecithin.—Lecithin is a nitrogenous body, allied both to the fats and proteids and containing glycerol and phosphoric acid. Its percentage composition is represented with some accuracy by the formula C₄₂H₈₆NPO₉, or according to Hoppe-Seyler, C₄₄H₉₀NPO₉. It appears to be a compound of cholin with glycerolphosphoric acid. It is widely distributed both in animal and vegetable organisms, in the latter especially in pease and beans.
From a physiological point of view, lecithin is highly important as the medium for the passage of phosphorus from the organic to the inorganic state, and the reverse. This function of lecithin has been thoroughly investigated in this laboratory by Maxwell.[359]
In the extraction of lecithin from seeds (pease, beans, etc.) it is not possible to secure the whole of the substance by treatment with ether alone.[360]
The extraction of the lecithin may, however, be entirely accomplished by successive treatments for periods of about fifteen hours with pure ether and alcohol. This is better than to mix the solvents, since, in this case, the ether having the lower boiling point is chiefly active in the extraction. When the extraction is accomplished by digestion and not in a continuous extracting apparatus the two solvents may be mixed together and thus used with advantage. After the evaporation of the solvents, the lecithin is ignited with mixed sodium and potassium carbonate whereby the organic phosphorus is secured without loss in an inorganic form. Where greater care is desired, the method described for organic phosphorus in soils may be used.[361] The inorganic phosphorus thus obtained is estimated in the usual way as magnesium pyrophosphate. [Pg 431]
For analytical purposes, the extraction of lecithin from vegetable substances is conducted in this laboratory as follows:[362] The fine-ground pea or bean meal is placed in an extraction apparatus and treated continuously with anhydrous ether for fifteen hours. The ether in the apparatus is replaced with absolute alcohol and the extraction continued for six hours longer. The alcoholic extract is evaporated to dryness and treated with ether. The part of the lecithin at first insoluble in ether becomes soluble therein after it has been removed from the vegetable tissues by alcohol. Moreover, any trace of inorganic phosphorus which may have been removed by the alcohol, is left undissolved on subsequent treatment with ether. The ether extract from the alcohol residue is added to that obtained directly, the ether removed by evaporation, and the total lecithin oxidized and the residue used for the estimation of phosphorus as already described.
In determining the lecithin in eggs, the procedure employed for vegetable tissues is slightly changed.[363] The whole egg, excluding the shell, is placed in a flask with a reflux condenser and boiled for six hours with absolute alcohol. The alcohol is then removed from the flask by evaporation and the residue treated in like manner with ether for ten hours. The ether is removed and the dry residue rubbed to a fine powder, placed in an extractor and treated with pure ether for ten hours. The extract thus secured is oxidized after the removal of the ether by fusion with mixed alkaline carbonates and the phosphorus determined in the usual way.
390. Factor for Calculating Results.—The percentage of lecithin is calculated from the weight of magnesium pyrophosphate obtained by multiplying it by the factor, 7.2703.[364] This factor is calculated from the second formula for lecithin given above, in which the percentage of phosphorus pentoxid, P₂O₅, is 8.789.
Example.—In fifty-four grams of egg, exclusive of the shell, is found an amount of organic phosphorus yielding 0.0848 gram of magnesium pyrophosphate. Then 0.0848 × 7.2703 = 0.61652 and 0.61652 × 100 ÷ 54 = 1.14. Therefore the percentage of lecithin in the egg is 1.14.
[Pg 432] 391. Estimation of Alkaloidal Nitrogen.—The alkaloids contain nitrogen in a form more difficult of oxidation than that contained in proteid or albuminoid forms. It is doubtful whether any of the nitrogen in alkaloids becomes available for plant nutrition by any of the usual processes of fermentation and decay to which nitrogenous bodies are submitted in the soil. Likewise, it is true that it is not attacked by the digestive processes in any way preparatory to its assimilation as food by the animal tissues. Alkaloidal nitrogen is therefore not to be regarded as a food either for the animal or plant.
For the general methods of estimating alkaloids the reader is referred to standard works on plant chemistry and toxicology. The alkaloids of interest in this manual are those which are found in tobacco, tea, coffee and a few other products of agricultural importance. The best methods of isolating and estimating these bodies will be given in the part of the volume devoted to the special consideration of the articles mentioned.
392. Preliminary Treatment.—The chief disturbing components of vegetable tissues, in respect of their influence on the separation and estimation of the proteid constituents, are fats and oils and coloring matters. In many cases these bodies are present in such small quantities as to be negligible, as, for instance, in rice. In other cases they exist in such large proportions as to present almost insuperable difficulties to analytical operations, as is the case with oily seeds. In all instances, however, it is best to remove these bodies, even when present in small proportions, provided it can be done without altering the character of the proteid bodies. This is secured by extracting the fine-ground vegetable material first with petroleum ether, and afterwards with strong alcohol and ether. Practically, all of the fatty bodies and the greater part of the most objectionable coloring matters are removed by this treatment. The extraction should in all cases be made at low temperatures, not exceeding 35°, to avoid the coagulating effect of higher temperatures upon the albuminous bodies which may be present. [Pg 433]
In this laboratory, fatty seeds, as for instance peanuts, are first ground into coarse meal, then extracted with petroleum ether, ground to a fine meal and the fat extraction completed with petroleum ether, ninety-five per cent alcohol and pure sulfuric ether. The residue of the last solvent may be removed by aspirating air through the extracted meal. In some cases, it is advisable to extract with ethyl ether before as well as after the alcoholic extraction. This treatment removes at least a part of the water and prevents the dilution of the first part of alcohol added to such an extent as to make it dissolve some of the proteid matters. In each case, a portion of the alcoholic extract should be tested qualitively for proteid matter. If any be found, stronger alcohol should be used for, at least, the first extraction. A portion of the meal, prepared as above directed, is extracted with a ten per cent solution of sodium chlorid, as described further on, and a measured portion of the filtered extract diluted with water until the proteid matter in solution begins to be precipitated. By this treatment the proper strength of the salt solution, to be used for the subsequent extraction, is determined. To save time in dialyzing, the solution of salt employed as a solvent should be as dilute as possible.
The mixture of meal and solvent sometimes filters with difficulty. In these cases, it is advisable to first pour it into a linen bag from which the liquid portion can be removed by gentle pressure and subsequently filtered through paper. As a last resort, the liquid secured from the linen filter can be saturated with ammonium, zinc or magnesium sulfate, whereby all the proteid matters are thrown out. After filtering, the residue is again dissolved in salt solution and can then be readily filtered through paper.
The clear filtrate should be tested by fractional precipitation by heat and the final filtrate by acetic acid, as will be described further on.
The proteid matter may be further freed from amid compounds by treatment with copper sulfate.[365] This treatment is not advisable, however, except for the purpose of determining the total proteid nitrogen in the sample. The action of the [Pg 434] water, heat and cupric sulfate combined is capable of inducing grave changes in the character of the residual matter which would seriously interfere with the results of subsequent studies of the nature of the proteid bodies.
In many instances, as with cereal grains, the separation of the proteid bodies is accomplished by no further preliminary treatment than is necessary to reduce them to the proper degree of fineness.
393. Diversity of Character.—The proteids which occur in vegetable products are found in all parts of the tissues of the plants, but in cereals especially in the seeds. In grass crops and in some of the legumes, such as clover, the nitrogenous matters are chiefly found in the straw and leaves. The general classification of these bodies has already been given, but each kind of plant presents marked variations, not only in the relative proportions of the different classes, but also in variations in the nature of each class. For this reason the study of vegetable proteids is, in some respects, a new research for each kind of plant examined. There are, however, some general principles which the analyst must follow in his work, and an attempt will be made here to establish these and to construct thereon a rational method of conducting the investigation. In the separation and estimation of complex bodies so nearly related to each other, it is difficult not only to secure satisfactory results, but also to prevent the transformation of some forms of proteid matter into others nearly related thereto by the action of the solvents used for separation and precipitation.
394. Separation of Gluten from Wheat Flour.—The most important proteid in wheat is the body known as gluten, a commercial name given to the nitrogenous matters insoluble in cold water. The gluten thus obtained does not represent a single chemical compound, but is a complex consisting of at least two proteid bodies, which together form an elastic, pasty mass, insoluble in cold water containing a trace of mineral salts. This mass has the property of holding mechanically entangled among its particles bubbles of gas, which, expanding under the action of heat during cooking, give to bread made of glutenous flours its porous property. [Pg 435]
In respect of proteids, the American wheats, as a rule, are quite equal to those of foreign origin. This is an important characteristic when it is remembered that both the milling and food values of a wheat depend largely on the nitrogenous matter which is present. It must not be forgotten, however, that merely a high percentage of proteids is not always a sure indication of the milling value of a wheat. The percentage of gluten to the other proteid constituents of a wheat is not always constant, and it is the gluten content of a flour on which its bread making qualities chiefly depend. The percentage of moist gluten gives, in a rough way, the property of the glutenous matter of absorbing and holding water under conditions as nearly constant as can be obtained. In general, it may be said that the ratio between the moist gluten and the dry gluten in a given sample is an index for comparison with other substances in the same sample. Upon the whole, however, the percentage of dry gluten must be regarded as the safer index of quality. In respect of the content of glutenous matter, our domestic wheats are distinctly superior to those of foreign origin. They are even better than the Canadian wheats in this respect. It may be fairly inferred, therefore, that while our domestic wheats give a flour slightly inferior in nutritive properties to that derived from foreign samples, it is nevertheless better adapted for baking purposes, and this quality more than compensates for its slight deficiency in respect of nutrition, a deficiency, which, however, is so minute as to be hardly worth considering.[366]
The gluten is separated in this laboratory from the other constituents of a flour by the following process:
Ten grams of the fine-ground flour are placed in a porcelain dish, well wet with nearly an equal weight of water at a temperature of not to exceed 15°, and the mass worked into a ball with a spatula, taking care that none of it adheres to the walls of the dish. The ball of dough is allowed to stand for an hour, at the end of which time it is held in the hand and kneaded in a stream of cold water until the starch and soluble matter are removed. The ball of gluten thus obtained is placed in cold water and allowed to remain for an hour when it is removed, pressed as dry as possible between the hands, rolled into a ball, [Pg 436] placed in a flat bottom dish and weighed. The weight obtained is entered as moist gluten. The dish containing the ball of gluten is dried for twenty hours in a steam-bath, again weighed, and the weight of material obtained entered as dry gluten. The determination of dry and moist gluten cannot in any sense be regarded as an isolation and estimation of a definite chemical compound. For millers’ and bakers’ purposes, however, the numbers thus obtained have a high practical value. A typical wheat grown in this country will contain about 26.50 per cent of moist and 10.25 per cent of dry gluten.
The gluten of wheat is composed of two proteid bodies, gliadin and glutenin.[367] Gliadin contains 17.66 per cent, and glutenin 17.49 per cent of nitrogen. Gliadin forms a sticky mass when mixed with water and is prevented from passing into solution by the small content of mineral salts present in the flour. It serves to bind together the other ingredients of the flour, thus rendering the dough tough and coherent. Glutenin serves to fix the gliadin and thus to make it firm and solid. Glutenin alone cannot yield gluten in the absence of gliadin, nor gliadin without the help of glutenin. Soluble metallic salts are also necessary to the formation of gluten, and act as suggested above, by preventing the solution of the gliadin in water, during the process of washing out the starch. No fermentation takes place in the formation of gluten from the ingredients named.
The gluten, which is obtained in an impure state by the process above described, is, therefore, not to be regarded as existing as such in the wheat kernel or flour made therefrom, but to arise by a union of its elements by the action of water.
395. Extraction with Water.—It is quite impossible to get an extract from fine-ground vegetable matter in pure water because the soluble salts of the sample pass at once into solution and then a pure water solvent becomes an extremely dilute saline solution. The aqueous extract may, however, be subjected to dialysis, whereby the saline matter is removed and the proteid matter, not precipitated during the dialytic process, may be regarded as that part of it in the original sample soluble in pure water. Nevertheless, in many instances, it is [Pg 437] important to obtain an extract with cold water. In oatmeal the aqueous extract is obtained by Osborne as follows:[368] Five pounds of fine-ground meal are shaken occasionally with six liters of cold water for twenty-four hours, the liquid removed by filtration and pressure and the extraction continued with another equal portion of water in the manner noted. The two liquid extracts are united and saturated with commercial ammonium sulfate which precipitates all the dissolved proteid matter. The filtrate obtained is collected on a filter, washed with a saturated solution of ammonium sulfate and removed as completely as possible from the filter paper by means of a spatula. Any residual precipitate remaining on the paper is washed into the vessel containing the removed precipitate and the undissolved precipitate well beaten up in the liquid, which is placed in a dialyzer with a little thymol, to prevent fermentation, and subjected to dialysis for about two weeks. At the end of that time, the contents of the dialyzer are practically free of sulfates. The contents of the dialyzers are then thrown on a filter and in the filtrate are found those proteids first extracted with water, precipitated with ammonium sulfate and redissolved from this precipitated state by pure water. In the case of oatmeal, this proteid matter is not coagulated by heat, and may be obtained in the dry state by the evaporation of the filtrate last mentioned at a low temperature in vacuo. It is evident that the character of the proteid matter thus obtained will vary with the nature of the substance examined. In the case of oats, it appears to be a proteose and not an albumin.
396. Action of Water on Composition of Proteids.—When a body, such as oatmeal, containing many proteids of nearly related character, is exposed to the action of a large excess of water, the proteid bodies may undergo important changes whereby their relations to solvents are changed. After oatmeal has been extracted with water, as described above, the proteid matter originally soluble in dilute alcohol undergoes an alteration and assumes different properties. The same remark is applicable to the proteid body soluble in dilute potash. Nearly all the proteid matter of oatmeal is soluble in dilute potash, if [Pg 438] this solvent be applied directly, but if the sample be previously treated with water or a ten per cent salt solution the subsequent proportion of proteid matter soluble in dilute potash is greatly diminished.[369] Water applied directly to the oatmeal apparently dissolves an acid albumin, a globulin or globulins, and a proteose. The bodies, however, soluble in water, exist only in small quantities in oatmeal. Experience has shown that in most instances, it is safer to begin the extraction of a cereal for proteid matter with a dilute salt solution rather than with water, and to determine the matters soluble in water alone by subsequent dialysis.
397. Extraction with Dilute Salt Solution.—In general, it is advisable to begin the work of separating vegetable proteids by extracting the sample with a dilute brine usually of ten per cent strength. As conducted by Osborne and Voorhees, on wheat flour, the manipulation is carried on as follows:[370]
The fine-ground whole wheat flour, about four kilograms, is shaken with twice that weight of a ten per cent sodium chlorid solution, strained through a sieve, to break up lumps, and allowed to settle for sixteen hours. At the end of this time, about half of the supernatant liquid is removed by a siphon or by decantation and filtered. Two liters more of the salt solution are added, the mixture well stirred and the whole brought onto the filter used above. The filtrate is collected in successive convenient portions and each portion, as soon as it is obtained, is saturated with ammonium sulfate. All the proteid matter is precipitated by this reagent. The precipitate is collected on a filter, redissolved in a convenient quantity of the salt solution and dialyzed for fourteen days or until all sulfates and chlorids are removed. The proteid matter, which is separated on dialysis, in this instance, is a globulin.
The proteid matter not precipitated on dialysis is assumed to be that part of the original substance soluble in water.
A part of the water soluble proteid matter obtained as above is coagulated by heat at from 50° to 80°. The part not separated by heat gives a precipitate on saturation with sodium chlorid.
In wheat there are found soluble in water two albumins and a proteose.[371]
[Pg 439] In separating the albumin coagulating at a low boiling point from the dialyzed solution mentioned above, it is heated to 60° for an hour, the precipitate collected on a gooch, washed with hot water (60°), and then successively with ninety-five per cent alcohol, water-free alcohol and ether. On drying the residual voluminous matter on the filter over sulfuric acid, it becomes dense and horny, having in an ash free state, according to Osborne, the following composition:
| Per cent. | |
| Carbon | 53.06 |
| Hydrogen | 6.82 |
| Nitrogen | 17.01 |
| Sulfur | 1.30 |
| Oxygen | 21.81 |
398. Treatment without Precipitation with Ammonium Sulfate.—Where abundant means are at hand for dialyzing large volumes of solution, the preliminary treatment of the solution made with ten per cent sodium chlorid with ammonium sulfate may be omitted.
When the precipitated proteids are to be used for the estimation of the nitrogen therein contained, it has been proposed to substitute the corresponding zinc salt for the ammonium sulfate.[372] This reagent has given satisfactory results in this laboratory and while a larger experience is desirable before commending it as an acceptable substitute in all cases, yet its obvious advantage, in being free of nitrogen for the use mentioned, entitles it to careful consideration.
The manipulation, with the exception of the precipitation with ammonium sulfate, is the same as that described in the preceding paragraph. The globulins are completely precipitated when the dialysis is complete and may be separated from the soluble albumins and proteoses by filtration.
399. Separation of the Bodies Soluble in Water.—Albumins.—By the methods of treatment just described, the proteid matters soluble in ten per cent sodium chlorid solution are separated into two classes, viz., globulins insoluble in pure water and albumins and proteoses soluble in pure water. The aqueous solution will also contain any amids or nitrogenous [Pg 440] bases soluble in the dilute saline solution and in water. Osborne and Voorhees have found that the best way of separating the albumins in the pure aqueous solution is by the application of heat.[373] By means of a fractional coagulation the albumins are divided into classes, viz., those separating at from 60° to 65° and those remaining in solution at that temperature but separating up to 85°. The respective quantities of these albumins are determined by collecting them in a filter and estimating the nitrogen therein by moist combustion in the usual way. Even a larger number of albumins may be secured, as in the maize kernel, by such a fractional precipitation by means of heat. Chittenden and Osborne find in this instance that the precipitation begins at about 40°.[374]
Proteose.—After the separation of the albumins by heat the filtrate may still contain proteid matter. This matter belongs to the proteose class. It may be partially secured by concentrating the filtrate, after the removal of the albumins, to a small bulk when a part of the proteose body will separate. It may be thrown out entirely by treating the filtrate above mentioned with fine-ground salt until it is saturated or by adding salt until the solution contains about twenty per cent thereof and precipitating the proteose by acetic acid.[375]
400. Separation of the Globulins.—The globulins which are extracted with ten per cent solution of sodium chlorid and precipitated on dialysis may be separated by fractional solution into several bodies of nearly related properties. This solution is conveniently accomplished by saline solvents of increasing strength. In the case of the maize globulins, Chittenden and Osborne employ dilute solutions of common salt for effecting the separation, beginning with a quarter of a per cent and ending with a two per cent mixture.[376]
401. Proteids Soluble in Dilute Alcohol.—Some of the proteid bodies which are soluble in dilute salt solution and in water are also soluble in alcohol. Since these bodies are more easily identified by the processes already described, attention will be given in this paragraph solely to those proteid bodies which are insoluble in water or dilute salt solution and are soluble in dilute alcohol. [Pg 441]
For the extraction of these bodies, the residue, left after extraction with a ten per cent solution of sodium chlorid or with water, is mixed with enough strong alcohol to secure by the admixture with the water present in the sample an alcohol of about seventy-five per cent strength. The mixture is well shaken and digested for some time, at a temperature of about 46°, and thrown on a filter which is kept at about the same temperature. The residue is again mixed with alcohol of the same strength (seventy-five per cent) using about four liters for two and a half kilos of the original material. During the second digestion the temperature is kept at about 60°. The latter operation is repeated three times and in each case the filtrate obtained is evaporated separately.[377] This process is especially applicable to the meal from maize kernels, which contains a high relative percentage of an alcohol soluble proteid, zein.
The chief part of the zein is found in the first two extracts, obtained as described above. On evaporation, the zein separates as a tough, leathery, yellow-colored mass on the walls of the containing vessel. It is cut into small pieces and digested for several days in cold, pure alcohol. This is followed by digestion with a mixture of ether and pure alcohol, and finally with pure ether. By this treatment a part of the zein becomes insoluble in seventy-five per cent alcohol. The part soluble in dilute alcohol is precipitated by pouring it into water.
Another method of preparing zein is to extract the meal with seventy-five per cent alcohol after it has been treated with a ten per cent salt solution.
In this case the extraction is continued with seventy-five per cent alcohol in successive portions until no more proteid matter passes into solution. The several extracts are united and the alcohol removed by distillation, by which process the zein is separated. It is washed with distilled water, until the sodium chlorid is removed, dissolved in warm alcohol of about eighty per cent strength and any insoluble matter removed by filtration. On evaporating the filtrate nearly to dryness, the zein is separated and pressed as free of water as possible, yielding a yellow, elastic substance resembling molasses candy. This preparation is purified by digestion with pure alcohol and ether in the [Pg 442] manner described. The two zeins which are secured by the treatment, one soluble and the other insoluble in alcohol, are practically identical in composition.[378]
Zein freshly precipitated by pouring its alcoholic solution in water is wholly insoluble in water, and, on boiling therewith, is changed into the variety insoluble in dilute alcohol. Boiled with dilute sulfuric acid, six in 300 cubic centimeters of water, it melts, forming a gummy mass, which is very slowly attacked by the acid yielding proteoses and peptones. Heated with stronger sulfuric acid it undergoes decomposition, yielding leucin, tyrosin, and glutamic acid.
402. Solvent Action of Acids and Alkalies.—In the preceding paragraphs, a synopsis has been given of the methods of separating proteid matters in such a manner as to secure them in a pure state in the same conditions as they exist in the natural substances. A very large percentage of the proteid matter is still left undissolved after extraction with the solvents already mentioned.
Often important information may be gained concerning the nature of the residual proteid matters by fractional extraction with dilute acids and alkalies. When the strength of these solutions is such that they contain about one per cent of the acid or alkali, the whole of the proteid matter may be dissolved by boiling successively with acid and alkali for half an hour. The proteid matter passing into solution in these cases is usually changed in character, assuming the nature of proteoses or allied bodies, when treated with an acid, and becoming albuminates when boiled with an alkali. Easily soluble carbohydrate matter is also removed by this treatment so that the residue obtained consists largely of cellulose and is known as crude or insoluble fiber. The removal of all the bodies soluble in dilute boiling acid and alkali is accomplished by the method described in paragraph 272.
For research purposes, the solvent action of dilute alkali is of chief importance to the analyst, and the extraction of the proteid matter, after all that is soluble in water, common salt solution and alcohol [Pg 443] has been removed, should commence with a solution of potassium or sodium hydroxid containing not over two-tenths per cent of the alkali.
It has been shown by Osborne that the solvent action of very dilute alkali, in the cold, may be exerted without changing the character of the dissolved proteid.[379]
403. Method of Extraction.—The solvent employed is usually a two-tenths per cent solution of potassium hydroxid. It may be added directly to the substance or may follow extraction with water, salt solution or alcohol. In the former case, the manipulation is illustrated by the following description of the treatment of oatmeal:[380]
One hundred grams of oatmeal are mixed with half a liter of a two-tenths per cent potassium hydroxid solution and allowed to stand for some time at room temperature. The mixture is strained through a cloth to remove the chaff and the residue is stirred with another small portion of the solvent, again strained in the same cloth and the residue squeezed dry. The strained liquids are united and enough more of the solvent added to make the volume 700 cubic centimeters. After standing for some time, the insoluble matter settles to the bottom of the vessel and the supernatant liquid is decanted. More solvent is added to the residue, well mixed therewith and treated as above. It is advisable to make a third extraction in the same way. The extracts are united, passed through a filter, the proteid matter in solution thrown out by acetic acid, washed with water, alcohol and ether and dried over sulfuric acid.
The methods of procedure, when the sample has been previously extracted with water, salt solution or alcohol, are essentially the same as that just described and the reader may consult the paper of Osborne for details.[381]
404. Methods of Drying Separated Proteids.—In the preceding paragraphs, the analyst has been directed, in most instances, to dry the proteid matter, after it is secured in as pure a form as possible, at room temperature, over sulfuric acid. By this treatment the preparation may be obtained in a form suited to the study of its physical properties, since its solubility has not been affected by [Pg 444] subjecting it to a high temperature. When it is desired to use the sample only for chemical analysis it is not necessary to wait on the slow process above mentioned. In this case the sample may be dried in an inert atmosphere at the temperature of a steam-bath or even at 110°. It is better, however, to avoid so high a temperature and to conduct the desiccation in vacuo at a heat not above that of boiling water. The sample, before drying, should be reduced to the finest possible state of comminution, otherwise particles of aqueous vapor may be retained with great tenacity.
In many cases it is advisable to dry the sample pretty thoroughly, then grind to a fine powder and finish the desiccation with the pulverulent mass. This treatment can be followed when the quantity of the material is considerably in excess of that required for the analytical operations.
405. Determination of Ash.—No method of treatment is known by means of which vegetable proteid matters may be obtained entirely free of mineral matters. The mineral bases may be naturally present in the proteid matter as organic and inorganic salts, or they may be mechanically entangled therewith, having been derived either from the other tissues of the plant or from the solvents employed. It is necessary in calculating the analytical data to base the computation on the ash free substance. The percentage of ash is determined by any of the standard processes or by heating the sample in a combustion tube, to very low redness, in a current of oxygen. The total residue obtained is used in calculating the percentage of ash, and the weights of material subsequently used for the determination of carbon, hydrogen, nitrogen and sulfur are corrected for the calculations by deducting the quantity of mineral matter contained therein.
By reason of the highly hygroscopic nature of the dry proteid bodies, they must be kept over a desiccating material and weighed quickly on a balance, in an atmosphere which is kept free of moisture by the usual methods.
406. Carbon and Hydrogen.—Carbon and hydrogen are estimated in proteid matters by combustion with copper oxid. Osborne prefers to burn the sample in a platinum boat in a current of air or of oxygen free of [Pg 445] moisture and carbon dioxid.[382] It is advisable to use also a layer of lead chromate in addition to the copper oxid and metallic copper. The method of conducting the combustion has already been described.[383] The analyst should have at his disposal a quantity of pure sugar, which may be used from time to time in testing the accuracy of the work. In beginning a series of combustions this precaution should never be omitted. The addition of the lead chromate is to make more certain the absorption of oxidized sulfur produced during the combustion.
407. Estimation of Nitrogen.—In most cases it is found convenient, during the progress of separating vegetable proteids, to determine the quantity of each kind by estimating the nitrogen by moist combustion and computing the quantity of proteid matter by multiplying the nitrogen by 6.25. The estimation of the nitrogen is made either on an aliquot part of the extract or by direct treatment of the residue.
In the pure extracted proteid matter the nitrogen is most conveniently determined by moist combustion, but it may also be obtained either by combustion with soda-lime or with copper oxid, or by other reliable methods.[384]
The percentages of nitrogen found in the principal proteid bodies, together with the factors for computing the weights of the proteid bodies from the weights of nitrogen found, are given below:
| Name of body. | Percentage of nitrogen. | Factor. |
|---|---|---|
| Mucin | 13.80 to 14.13 | 7.25 to 7.08 |
| Chondrin | 14.20 to 14.65 | 7.04 to 6.83 |
| Albuminates | 13.87 | 7.21 |
| Oat proteids | 15.85 | 6.31 |
| Serum globulin | 15.63 | 6.40 |
| Egg albumin | 15.71 to 17.85 | 6.37 to 5.60 |
| Maize proteids | 16.06 | 6.22 |
| Casein | 15.41 to 16.29 | 6.49 to 6.13 |
| Serum albumin | 15.96 | 6.27 |
| Syntonin | 16.10 | 6.21 |
| Keratin | 16.20 to 17.70 | 6.17 to 5.65 |
| Fibrinogen | 16.65 | 6.01 |
| Peptones | 16.66 to 17.13 | 6.00 to 5.84 |
| Elastin | 16.75 | 5.97 |
| Wheat proteids | 16.80 to 18.39 | 5.95 to 5.44 |
| Fibrin | 16.91 | 5.91 |
| Flax seed proteids | 17.70 to 18.78 | 5.65 to 5.33 |
[Pg 446] 408. Determination of Sulfur.—Sulfur is a characteristic constituent of the proteid bodies, existing in quantities approximating one per cent of their weight.
In the estimation of sulfur, it is first converted into sulfuric acid, which is thrown out by a soluble barium salt and the sulfur finally weighed as barium sulfate.
All the sulfur existing in the organic state in a proteid may be obtained by burning in a current of oxygen and conducting the gaseous products of combustion through solid sodium or potassium carbonate at or near a red heat.[385] The organic sulfur may also be converted into sulfuric acid by fusing the proteid body with a mixture of sodium hydroxid and potassium nitrate. The fused mass, after cooling, is dissolved in water, the solution acidified with hydrochloric, evaporated to dryness to decompose nitrates and remove excess of hydrochloric acid and dissolved in a large excess of water. After standing for a day, the solution is filtered and the sulfuric acid thrown out of the hot filtrate with a slight excess of barium chlorid solution. The usual precautions in precipitating, filtering and igniting the barium sulfate are to be observed.[386]
409. General Observations.—In the preceding paragraphs have been stated the general principles upon which the separation of vegetable proteid matters depends, and a description has been given of the several processes by which this separation is accomplished. In each case, however, special conditions exist which require special modifications of the general processes, and these can only be successfully secured by the skill, judgment and patient labor of the investigator. Many of these cases have been already worked out, and the valuable data secured by Chittenden, Osborne and others, are accessible to the analyst in the papers already cited. In the case of the proteids in the peanut, a similar work has been done in this laboratory by Bigelow, the data of which have not yet been published. It is only by a careful study of the work already done as outlined here and as published in full in the cited papers, that the analyst will be able to secure trustworthy guidance for future investigations. [Pg 447]
410. Dialysis.—One of the most important of the operations connected with the separation and analysis of proteids is the removal of the salts whereby their solutions are secured. This is accomplished by subjecting the solutions of the proteid matters to dialysis. The solution is placed in bags made of parchment dialysis paper. These bags are tied about a glass tube, whereby access may be had to their contents during the progress of the work. Since the volume of the liquid increases during the process, the bags should not be filled too full in the beginning.

Fig. 105. Dialyzing Apparatus.
In this laboratory the dialysis is carried out by Bigelow with the city water from the Potomac, which is first passed through a battery of porous porcelain filtering tubes to remove any suspended silt or micro-organisms. If unfiltered water be used, the germs therein cause a fermentation in the proteid matter, which seriously interferes with the value of the data obtained, and which can only be avoided by the use of an antiseptic, such as an alcoholic solution of thymol. Even with filtered water, the use of a few drops of the solution mentioned is often necessary. To avoid the use of too great quantities of the filtered water, the dialyzers are arranged en batterie, as shown in the figure. The filtered water enters the first vessel and thence [Pg 448] passes through all. The parchment bags are frequently changed from vessel to vessel, each being brought successively into the first vessel in contact with the fresh water. In some cases the final steps in the dialysis may be accomplished in distilled water.
It is advisable to conduct a fractional preliminary dialysis of the salt solution containing proteids in such a way as to secure the globulins precipitated in each interval of twenty-four hours. Each portion thus secured may be examined with the microscope. Usually a period of two weeks is required to entirely remove the mineral salts from solution. If prepared parchment tubes be used for the dialysis, they should be first tested for leaks, and should not be more than half filled. By the use of a large number of these tubes a greater surface is exposed to dialytic action, and the time required to complete the operation is correspondingly decreased.
411. Preparation of the Sample.—Animal products present many difficulties in respect of the reduction thereof to a sufficiently comminuted condition for analytical examination. In the case of bones, the choppers used for preparing them for feeding to fowls are the most efficient apparatus for reducing them to fragments. In this condition they may be ground to a finer state in a sausage machine. The flesh of animals may be reduced by this machine, with two or three grindings, to a fairly homogeneous mass. Subsequent grinding in a mortar with powdered glass or sharp sand may serve to reduce the sample to a finer pulp, but is not usually necessary and should be avoided when possible. The sample thus prepared serves for the estimation of water, ash and fat by methods already described. The sample should be prepared in quantities of considerable magnitude, the whole of any organ or separate portion of the body being used when possible. In examining the whole body the relative weights of blood, bones, viscera, muscle, hide and other parts should first of all be ascertained and noted.
412. Treatment of Muscular Tissues for Nitrogenous Bodies.—For [Pg 449] the present purpose a brief sketch of the method of separating the nitrogenous bodies in the muscular tissues of the body is all that can be attempted. For methods of examining the different organs and parts of the body in greater detail, standard works on physiological chemistry may be consulted.[387]
Extraction with Cold Water.—A noted quantity of the finely divided tissues is mixed with several volumes of ice cold water and well rubbed occasionally for several hours, the temperature meanwhile being kept low. The mixture is poured into a linen bag and the liquid portion removed by gentle pressure. The residue in like manner is treated with fresh portions of cold water until it gives up no further soluble matters. An aliquot portion of the extract is concentrated to a small bulk and serves for the determination of total nitrogen. The methods of separating and estimating nitrogenous bodies in flesh soluble in water will be given in considerable detail further on.
Extraction with Ammonium Chlorid and Hydrochloric Acid.—The residue, after exhaustion with cold water, is extracted with a solution of ammonium chlorid containing 150 grams of the salt in a liter. This method of extraction is entirely similar to that with water just described. Globulins and myosin pass into solution by this treatment. The residual mass is washed as free as possible of the solvent and is then further extracted with dilute hydrochloric acid containing four cubic centimeters of the fuming acid in a liter. The treatment with dilute acid is continued until no further substance passes into solution. This is determined by neutralizing a portion of the extract with sodium carbonate, or by the direct addition of potassium ferrocyanid. In either case absence of a precipitate indicates that no nitrogenous matters are present in the solution.
Extraction with Alkali.—The residue from the acid extraction is washed with water until the acid is removed and then extracted in a similar manner with a dilute solution of sodium or potassium hydroxid containing not to exceed two grams of the caustic to the liter. When this residue is finally washed with water and a little acetic acid, it will be found that practically all the purely albuminous bodies contained in the tissues have been extracted with the exception of any [Pg 450] fibrin, which the blood, present in the tissues at the commencement of the extraction, may have contained. The extract should be acidified with acetic as soon as obtained.
Extraction with Boiling Water.—The residual matter boiled for some time with water will part with its collagen, which, when transformed by the heat into glutin, passes into solution.
The sarcolemma, membranes, elastic fibers and keratin remain undissolved.
413. Contents of the Several Extracts.—By the systematic treatment of muscular tissues in the manner just described, the nitrogenous bodies they contain are separated into five classes, viz.:
Cold Water Extract.—This contains serum albumin, serum globulin, muscle albumin, myosin, mucin and peptone.
Ammonium Chlorid Extract.—This solution contains the globulins and also in many cases some myosin and serum globulin.
Hydrochloric Acid Extract.—When the extractive matter removed by hydrochloric acid, thrown out by sodium carbonate and well washed with water, has a neutral reaction, it consists of syntonin, when acid, of an albuminate.
Alkali Extract.—The acid albumin of the animal tissue is found in the alkaline solution and may be thrown out by making the solution slightly acid.
Insoluble Residue.—The fifth class contains the insoluble nitrogenous bodies mentioned above.
414. General Observations.—Only a brief résumé of the methods of treating animal tissues for nitrogenous bases is given above, since a more elaborate discussion of these principles and methods would lead too far away from the main purpose of this manual. For practical purposes, the most important of these bodies are those soluble in water and the methods of treating these will be handled at some length. Unfortunately, the methods of determining the exact qualities of these bodies are not as satisfactory in case of animal as in vegetable nitrogenous bodies. The flesh bases, soluble in water, contain a much larger percentage of nitrogen than is found in true proteid bodies, and [Pg 451] therefore the multiplication of the weight of nitrogen found therein by 6.25 does not give even a near approximation of the actual quantities of the nitrogenous bodies present in the sample.
Some of the flesh bases contain more than twice as much nitrogen as is found in proteids, and in such cases 3.12, and not 6.25, would be the more correct factor to use in the computation. When possible, therefore, these bodies should be precipitated and weighed after drying, but this is not practicable in many instances. The sole resource of the chemist in such cases is to determine the nature of the body as nearly as possible by qualitive reactions, then to determine the total nitrogen therein and multiply its weight by the corresponding factor. The principal flesh bases have the following percentages of nitrogen and the approximate factors for calculating analytical data are also given:
| Name of base. | Formula. | Per cent nitrogen. |
Factor. |
|---|---|---|---|
| Glutin | C₁₃H₂₀N₄O₅ | 17.95 | 5.57 |
| Carnin | C₇H₈N₄O₂ | 31.11 | 3.21 |
| Kreatin | C₄H₁₉N₃O₂ | 32.06 | 3.12 |
| Kreatinin | C₄H₇N₃O₂ | 37.17 | 2.69 |
| Sarkin | C₅H₄N₄O | 41.18 | 2.43 |
415. Composition of Meat Extracts.—The meat extracts of commerce contain all the constituents of meat that are soluble in warm water. The parts which are soluble in warm water and not in cold are found in the cold aqueous solution as suspended or sedimentary matters. Among the nitrogenous bodies present are included albumin, albumose and peptone among the proteids, carnin, kreatin, kreatinin, sarkin and xanthin among the non-proteids, and inosinic and uric acids and urea among other nitrogenous bodies. Among the non-nitrogenous bodies are found lactic and butyric acids, inosit and glycogen. Among mineral bodies occurs the phosphates and chlorids of the common bases. In addition to these bodies, meat extracts may also contain gelatin and other decomposition products of proteid matter. Since meat extract is supposed to be prepared by the digestion of the meat free of bones and put in cold water or in warm water not above 75°, the presence of [Pg 452] gelatin would indicate a different method of preparation, viz., either by boiling water or water heated above the boiling point under pressure. In a properly prepared extract, the percentage of gelatin is very small.
Approximately one-tenth of the whole nitrogen present is in the form of albumoses and only a trace as peptones. By far the greater part of the nitrogen exists as flesh bases (kreatin, etc.). The composition of three meat extracts, numbers one and two solid and number three liquid, is given in the subjoined table.[388]
| No. 1. Per cent. |
No. 2. Per cent. |
No. 3. Per cent. |
|||
|---|---|---|---|---|---|
| Total nitrogen | 9.28 | 9.14 | 2.77 | ||
| Nitrogen | as | albumin | trace | 0.08 | trace |
| ” | ” | albumose | 0.96 | 1.21 | 0.70 |
| ” | ” | peptone | trace | trace | none |
| ” | ” | flesh bases | 6.81 | 5.97 | 1.56 |
| ” | ” | ammonia | 0.47 | 0.41 | 0.09 |
| ” | in | compounds insoluble in | |||
| sixty-six per cent alcohol | 0.21 | 0.33 | 0.25 | ||
| ” | ” | other bodies | 0.83 | 1.14 | 0.17 |
417. Analysis of Meat Extracts.—The analysis of a meat extract should include the determination of the water, ash and total nitrogen. After multiplying the nitrogen which exists as proteids by 6.25 and adding together the percentages of all the ingredients, ash, water, etc., including ammonia, the sum is to be subtracted from 100 and the difference entered as non-nitrogenous organic matter. The nature of this conglomerate has already been explained.
Water.—It is advisable to determine the water in a partial vacuum (20) or in an atmosphere of hydrogen (23-25).
The water may also be determined in solid extracts by placing about five grams of the material in a flat bottom tin foil dish about fifty-five millimeters in diameter and twenty millimeters deep. The material is dissolved in enough warm water to fill the dish a little over one-half and the liquid is then absorbed by adding a weighed quantity of fibrous asbestos or of dry fragments of pumice stone. The asbestos is to be preferred because of the fact that it may be subsequently cut into small bits for the determination of the gelatin. [Pg 453] The dish thus prepared is dried to constant weight in a steam-bath or vacuum oven. The weight of the dish and of the added absorbent, together with that of the material employed and of the dried dish and its contents, give the data for calculating the percentage of water. The contents of the dish are used as described further on for the determination of gelatin. In liquid extracts the water is determined in an entirely analogous manner, using about twenty grams of the material and omitting the solution in water.
In solid extracts, the part insoluble in cold water is determined separately.
Ash.—The ash is determined by ignition at the lowest possible temperature, best in a muffle (28-32). The ash should be examined qualitively. Where a quantitive analysis is desired, larger quantities of the extract are incinerated and the constituents of the ash determined in the usual way.[389]
Total Nitrogen.—Since nitrates are not present unless added in the manufacture, the total nitrogen is best determined by moist combustion.[390]
Nitric Nitrogen.—The extract should be tested for nitrates and if present they are determined in the manner already described.[391]
Ammoniacal Nitrogen.—When ammonia is present it is determined by distillation with magnesia.[392]
Since boiling with magnesia may cause the distillation of more ammonia than is present as ammonium salts, the plus being due to the decomposition of some other nitrogenous compounds, Stutzer replaces the magnesia with barium carbonate.[393]
Proteid Nitrogen Insoluble in Sixty-Two Per Cent Alcohol.—The aqueous solution is treated with strong alcohol until the mixture contains about sixty-two per cent of the reagent. The precipitate produced is separated by filtration, washed with sixty-two per cent alcohol and the nitrogen therein determined.
Albumose Nitrogen.—This is secured by saturating the aqueous solution with zinc or ammonium sulfate. The separated albumoses are skimmed from the surface, thrown in a filter, washed with a saturated [Pg 454] solution of zinc sulfate and the nitrogen determined therein by moist combustion. In the filtrate from the above separation, peptone is detected qualitively by adding a few drops of dilute solution of copper sulfate (biuret reaction).
Kreatin, Kreatinin and Other Flesh Bases.—The clear, aqueous solution of the extract is acidified with sulfuric, mixed with a solution of sodium phosphotungstate and allowed to stand for about six days. The precipitate is collected, washed with a solution of the precipitant, and the nitrogen therein determined. The nitrogen found, less that due to ammonia, represents the total nitrogenous matter precipitated by the phosphotungstic acid. From this quantity is deducted the nitrogen in the proteids, precipitated by sixty-two per cent alcohol and by ammonium or zinc sulfate, and the remainder represents the nitrogen in flesh bases.
The nitrogen thrown out by the phosphotungstic acid is deducted from the total nitrogen, and the remainder represents the nitrogenous bodies not precipitable by the reagent named.
This method of separating the nitrogenous matters in meat extracts is based on the observation that these bodies contain at most only a small quantity of peptones, so small as to be safely negligible.[394]
Quantities used for Analysis.—In conducting the separations above noted, it will be found convenient to use in each case about five grams of the solid or twenty of the liquid extract. In the nitrogen determinations, the weight of the sample should be inversely proportional to its content of nitrogen.
417. Preparation of the Phosphotungstic Reagent.—The phosphotungstic reagent is conveniently prepared as follows:
Dissolve 120 grams of sodium phosphate and 200 of sodium tungstate in one liter of water and add to the solution 100 cubic centimeters of strong sulfuric acid. When the reagent is prepared for general purposes it is customary to acidify with nitric, but in the present instance, inasmuch as the precipitate is used for the determination of nitrogen, it is evident that sulfuric should be substituted for nitric acid. In [Pg 455] all cases the analyst must be assured of the strong acidity of the reagent, and in addition to this the solutions of proteid matter to which the reagent is added must first be made strongly acid with sulfuric.
418. Zinc Sulfate as Reagent for Separating Albumoses from Peptones.—When the albumoses are separated from the peptones, by precipitation with ammonium sulfate, there may be danger of some of this reagent adhering to the albumose, and in this way the quantity of nitrogen obtained on analysis may be increased. To avoid an accident of this kind Bömer replaces the ammonium by zinc sulfate.[395]
Since the precipitation of the albumoses by saturated saline solutions depends on their hydrolytic power, the substitution of another salt for ammonium sulfate capable of strongly attracting water, may be made if that salt does not possess any objectionable property. Crystallized zinc sulfate will dissolve in less than its own weight of cold water and is therefore well suited for the purpose in view.
In the case of a meat extract, the precipitation is accomplished as follows: Fifty cubic centimeters of the extract, freed from all solid matter by filtration and containing about two grams of the soluble proteids, are saturated in the cold with finely powdered zinc sulfate. The separated albumoses collect on the surface and are skimmed off, poured on a filter and washed with cold saturated zinc sulfate solution. The filter and its contents are used for the determination of nitrogen by moist combustion.[396]
The filtrate from the precipitated albumoses gives no biuret reaction, and, therefore, as in the use of ammonium sulfate, is free of albumin.
The biuret reaction is applied to the zinc sulfate filtrate as follows: The filtrate is greatly diluted with water and freed of zinc by means of a saturated solution of sodium carbonate. The filtrate free of zinc is evaporated on the steam-bath, made strongly alkaline with sodium hydroxid and treated with a few drops of a two per cent copper sulfate solution, added successively.
Another advantage possessed by the zinc sulfate is found in the fact [Pg 456] that in the filtrate from the separated albumoses the peptones and other flesh bases can be thrown out by phosphotungstic acid. Before the application of the reagent, the filtrate should be made strongly acid by adding about an equal volume of dilute sulfuric acid (one part of acid to four of water.)
The nitrogen in the precipitate thus obtained is determined by moist combustion in the manner already suggested.
If the proteid matters contain salts of ammonium it is probable that a difficultly soluble double sulfate of zinc and ammonium, (NH₄)₂SO₄.ZnSO₄.6H₂O, will be found in the precipitate. Ammonium salts, if present, should therefore be removed by distillation with magnesia. It is better, however, to throw down the ammonia with the first zinc precipitate, distil this with magnesia and determine the amount of nitrogen derived from the ammonia compounds. In a second sample, the total nitrogen is determined by moist combustion and the difference between the two results gives that due to albumoses.
419. Examination for Muscular Tissue.—Some samples of meat extracts contain small quantities of finely ground muscular tissue. For detecting this the extract is treated with cold water and the insoluble residue examined with a microscope. If muscular tissue be found, about eight grams of the extract or twenty-five of the fluid preparation, are treated with cold water, the insoluble matter collected upon a filter, washed with cold water, and the nitrogen determined in the residue. The percentage of nitrogen multiplied by 6.25 gives the quantity of muscle fiber proteids present. The filtrate from the above determination is acidified with acetic, boiled, any precipitate which is formed collected and the nitrogen therein determined. The nitrogen obtained multiplied by 6.25 gives the quantity of coagulable albumin present. An aliquot portion of the filtrate is used for the determination of nitrogen and the percentage therein found, deducted from the total nitrogen of the sample, gives a remainder which may be used as a representative of the whole of the nitrogen present in the form of albumin and muscular tissue.
420. Estimation of Gelatin.—The tin foil dish and its contents used for the determination of water, as above described, are cut into [Pg 457] small pieces, placed in a beaker and extracted four times with absolute alcohol. After the removal of the alcohol, the residue is extracted with ice water containing ten per cent of alcohol, in which a small piece of ice is kept to avoid a rise of temperature. The beaker should be shaken during the extraction, which should last for about two minutes. Where large numbers of samples are treated at once, any convenient form of shaking machine may be employed. At least two extractions with ice water must be made. The residue is then collected upon a filter and washed with ice water until the washings are completely colorless. The residue on the filter is replaced in the beaker, boiled with water, well washed on the filter with boiling water, the filtrate and washings concentrated and the nitrogen therein determined.
The principle of this determination is based on the fact that gelatin is almost completely insoluble in ice water while serum peptones and albumin peptones are almost completely soluble in that reagent. On the other hand, the flesh bases and the proteids present are almost completely removed by the preliminary treatment with alcohol and ice water or are left undissolved by the hot water. The solution in boiling water, therefore, contains practically nothing but gelatin.[397]
In a later article, Stutzer modifies the method given above as follows:[398]
Of dry and moist extracts from five to seven grams and of liquid extracts from twenty to twenty-five grams are used for the determination and placed in tin foil dishes, as described above. In case of solid extracts, a sufficient quantity of warm water is added to completely dissolve them, the solution being facilitated by stirring. In case the solution is too thin it should be concentrated before going further. It is treated with a sufficient amount of dust-free ignited sand to completely absorb it, and the dish and its contents are then dried to a constant weight. The dried contents of the dish are rubbed up in a mortar, the dish cut into fine bits, and all placed in a beaker. The solid syrphete[399] is extracted four times with 100 cubic centimeters of absolute alcohol, the alcohol in each case being poured through an asbestos filter for [Pg 458] the purpose of collecting any matters suspended therein. In a large flask are placed 100 grams of alcohol, 300 grams of ice and 600 grams of cold water, and the flask is placed in a large vessel and packed with finely divided ice. Four beakers marked b, c, d, e are also placed in ice and the beaker containing the syrphete, left after extraction with absolute alcohol as above mentioned, is marked a and also placed in pounded ice. The extraction with cold alcoholic water proceeds as follows:
In beaker a are poured 100 cubic centimeters of the mixture in the large flask, its contents are stirred for two minutes and then the liquid portion poured off into beaker b to which, at the same time, a piece of ice is added. In beaker a are poured again 100 cubic centimeters from the large flask, treated as above described, and the liquid extract poured into beaker c. In like manner the extraction in beaker a is continued until each of the beakers has received its portion of the extract. By this time the liquid over the sand in beaker a should be completely colorless. The filtration of the liquid extract is accomplished as follows:
In a funnel of about seven centimeters diameter is placed a perforated porcelain plate about four centimeters in diameter which is covered with asbestos felt with long fiber. Three filters are prepared in this way. On the first filter are poured the contents of beaker b. After the liquid has passed through, the sand and other residue in beaker a are transferred to the filter and the beaker and residue washed with the alcoholic ice water from the large flask. The filtration should be accomplished under pressure. On the second filter are poured the contents of beaker c. On the third filter the contents of beakers d and e. The washing with alcoholic ice water from the large flask is continued in each instance until the filtrate is colorless. At the same time the asbestos filter, which was used in the first instance for filtering the absolute alcohol extract, is washed with the alcoholic ice water mixture from the large flask. At the end the sand remaining in beaker a together with all the asbestos filters are brought together into a porcelain dish, boiled two or three times with water, the aqueous solution filtered and the filtrate concentrated and used for the estimation of the nitrogen. The quantity [Pg 459] of nitrogen found multiplied by 6.25 represents the proteid matter in the gelatin of the sample.
The object of the multiple filters, described above, is to accelerate the process, and they are required because the gelatin quickly occludes the filter pores. For this reason the asbestos filters are found to operate better than those made of paper. It should be mentioned that the residue of the peptones insoluble in alcohol may contain, in addition to gelatin, also small quantities of albumoses. From the quantity of albumose nitrogen found, it is understood that the nitrogen in the form of coagulable albumin, determined as described in the first process mentioned above, is to be deducted, since these coagulable albumins are insoluble in alcohol.
421. Estimation of Nitrogen in the Flesh Bases Soluble in Alcohol.—About five grams of the dry extract, ten grams of the extract containing water or twenty-five grams of the liquid extract are placed in a beaker and enough water added in each case to make about twenty-five cubic centimeters in all. Usually no water need be added to the liquid extracts. Very thin peptone solutions should be evaporated until the content of water is reduced to seventy-five per cent. The solution, prepared as above indicated, is treated slowly with constant stirring with 250 cubic centimeters of absolute alcohol, the stirring continued for some minutes and the vessel set aside for twelve hours, at the end of which time the precipitate is separated by filtration and washed repeatedly with strong alcohol. Leucin, tyrosin and a part of the flesh bases are dissolved by alcohol. The alcohol is removed by distillation and the residue dissolved in water. Any flocky residue which remains on solution with water is removed by filtration, the nitrogen determined therein and the quantity thereof added to the albumose nitrogen found, as hereafter described.
The volume of the aqueous solution is completed with water to half a liter. One hundred cubic centimeters of this solution are used for the determination of total nitrogen, and another 100 cubic centimeters for the determination of ammoniacal nitrogen by distillation with barium [Pg 460] carbonate. A part of the ammonia may have escaped during the preliminary distillation of the alcohol and therefore the amount found may not represent the whole amount originally present. The use of the above determination is principally to ascertain the correction to be made in the amount of total nitrogen found in the first 100 cubic centimeters of the solution.
422. Treatment of the Residue Insoluble in Alcohol.—The residue insoluble in alcohol is washed from the filter into the beaker in which the first solution was made. The aqueous mixture is warmed on a water-bath until the alcohol adhering to the precipitate is completely evaporated, when the contents of the beaker are poured upon a filter free of nitrogen. A small part of the albumose, by reason of the treatment with alcohol, tends to remain undissolved, and it is advisable to collect this albumose upon a filter, wash it well with hot water and estimate the nitrogen therein. The quantity of nitrogen thus found is to be added to the albumose nitrogen determined as described later on.
The total filtrate obtained from the last filtration is made up to a volume of half a liter, of which fifty cubic centimeters are used for the determination of total nitrogen, fifty cubic centimeters for the determination of gelatin, albumose and peptone, and 100 cubic centimeters for the residual peptones. The albumose, together with the gelatin and peptones carried down with it, is precipitated with zinc or ammonium sulfate solution, and its per cent calculated from the amount of nitrogen found in the precipitate. The true peptone is determined by subtracting the quantity of nitrogen determined as albumose from the total nitrogen in solution.
The rest of the liquid, viz., 300 cubic centimeters, is evaporated to a small volume and tested qualitively for true peptones as follows:
To separate the albumose and gelatin a concentrated liquor is treated with an excess of finely divided ammonium sulfate so that a part of the salt remains undissolved. The separated albumose, gelatin and undissolved ammonium salts are collected on a filter, the filtrate mixed with a few drops of dilute copper sulfate solution and a [Pg 461] considerable quantity of concentrated soda or potash lye added. Care should be taken that the quantity of copper is not too great, otherwise the peculiar red coloration will be obscured by the blue color of the copper solution.
423. Pancreas Peptone.—The filtrate obtained as described above, by treating the portion of the material insoluble in alcohol with warm water, contains in addition to the albumose and gelatin the whole of the pancreas peptone which may be present. To separate this peptone, 100 cubic centimeters of the aqueous solution are evaporated in a porcelain dish until the volume does not exceed ten cubic centimeters. When cool, at least 100 cubic centimeters of a saturated cooled solution of ammonium sulfate solution are added, the mixture thoroughly stirred, the precipitate collected upon a filter and washed with a cold saturated solution of ammonium sulfate. The contents of the filter are dissolved in boiling water, the filter thoroughly washed and the filtrate and washings evaporated in a porcelain dish with the addition of barium carbonate until, on the addition of new quantities of barium carbonate, no further trace of ammonia can be discovered. The residue is extracted with water, the barium sulfate and carbonate present separated by filtration, well washed and the nitrogen determined in the evaporated filtrate and washings in the usual way and multiplied by 6.25 to determine the quantity of pancreas peptone.
424. Albumose Peptone.—A part of the albumose peptone which may be present is determined in conjunction with the other bodies mentioned above. The chief quantity is found in the solution of the residue insoluble in alcohol in the following manner:
Fifty cubic centimeters of the solution of this residue in hot water are mixed with an equal volume of dilute sulfuric acid, one volume of acid to three of water, in the cold, and a solution of sodium phosphotungstate added until it produces no further precipitate. The precipitate is washed with dilute sulfuric acid and the nitrogen determined therein. The nitrogen thus found is derived from the albumose, pancreas peptone and gelatin. The quantity of nitrogen in the pancreas peptone and gelatin, as above described, is subtracted from [Pg 462] the total quantity found in the phosphotungstic acid precipitated, and the remainder represents the nitrogen due to the albumose.
425. Nitrogen in the Form of Flesh Bases Insoluble in Alcohol.—This is determined by subtracting the quantity of nitrogen, determined by the phosphotungstic acid method already described, from the total quantity of nitrogen found in the precipitate insoluble in alcohol and soluble in water.
[337] Watts’ Dictionary of Chemistry, new edition, Vol. 4, p. 327.
[338] Vid. op. cit. supra, p. 330.
[339] Barbieri, Journal für praktische Chemie, neue Folge Band 18, S. 114.
[340] Vid. op. cit. 1, p. 339.
[341] Bulletin No. 49, Kansas Experiment Station, May, 1895.
[342] This work, Vol. 2, p. 208.
[343] Vid. op. cit. supra, Vol. 1, p. 570.
[344] Wiley, American Chemical Journal, Vol. 6, No. 5, p. 289.
[345] Obermayer, Chemiker-Zeitung Repertorium, Oct. 1889, S. 269.
[346] Hoppe-Seyler, Handbuch der physiologisch- und pathologisch-chemischen Analyse, S. 269.
[347] Wiley, American Chemical Journal, Vol. 6, p. 289.
[348] Dragendorff’s Plant Analysis, p. 55.
[349] This work, Vol. 2, pp. 192 et seq.
[350] Chemiker-Zeitung, Band 20, S. 151.
[351] This work, Vol. 2, p. 207.
[352] Landwirtschaftlichen Versuchs-Stationen, Band 17, S. 321: Zeitschrift für analytische Chemie, Band 14, S. 380.
[353] Vid. op. cit. 12, p. 245.
[354] Landwirtschaftlichen Versuchs-Stationen, Band 16, S. 61.
[355] Berichte der deutschen chemischen Gesellschaft, Band 10, Ss. 85, 199; Band 16, S. 312: Chemiker-Zeitung, Band 20, S. 145.
[356] Zeitschrift für analytische Chemie, Band 22, S. 325.
[357] Richardson and Crampton, Berichte der deutschen chemischen Gesellschaft, Band 19, S. 1180.
[358] Maxwell, American Chemical Journal, Vol. 13, p. 470.
[359] Vid. op. cit. supra, Vol. 15, p. 185.
[360] Vid. op. cit. supra, Vol. 13, p. 13: Schulze, Zeitschrift physiologische Chemie, Band 14, S. 491.
[361] This work, Vol. I, p. 411.
[362] Vid. op. cit., 22, Vol. 13, p. 15.
[363] Vid. op. cit. supra, Vol. 15, p. 188.
[364] Hoppe-Seyler, Handbuch der physiologisch- und pathologisch-chemischen Analyse, S. 169.
[365] This work, Vol. 2, p. 225.
[366] Bulletin No. 45, Division of Chemistry, U. S. Department of Agriculture, p. 51.
[367] Osborne and Voorhees, American Chemical Journal, Vol. 15, p. 470.
[368] Vid. op. cit. supra, Vol. 13, p. 385.
[369] Vid. op. cit. supra, p. 412.
[370] Vid. op. cit. supra, Vol. 15, p. 402.
[371] Vid. op. cit. supra, p. 404.
[372] Zeitschrift für analytische Chemie, Band 34, S. 562.
[373] Vid. op. cit. 34, p. 404.
[374] Vid. op. cit. 3, p. 455.
[375] Osborne and Voorhees, vid. op. cit. 34, p. 409.
[376] Vid. op. cit. supra, Vol. 13, p. 464.
[377] Chittenden and Osborne, op. cit. supra, Vol. 14, p. 32.
[378] Vid. op. cit. supra, p. 41.
[379] Vid. op. cit. supra, p. 639.
[380] Vid. op. cit. supra, Vol. 13, p. 399.
[381] Vid. op. cit. supra, pp. 395, 400, 401.
[382] Vid. op. cit. supra, p. 409.
[383] This work, Vol. 1, p. 319.
[384] This work, Vol. 2, pp. 169 et seq.
[385] Vid. op. cit. 47, p. 420.
[386] Osborne, vid. op. cit. 44, p. 410.
[387] Hoppe-Seyler, Handbuch der physiologisch- und pathologisch-chemischen Analyse.
[388] König und Bömer, Zeitschrift für analytische Chemie, Band 34, S. 560.
[389] This work, Vol. 2, pp. 297, 298.
[390] Vid. op. cit. supra, p. 184.
[391] Vid. op. cit. supra, p. 206.
[392] This work, Vol. I, p. 450; Vol. 2, p. 226.
[393] Zeitschrift für analytische Chemie, Band 34, S. 377.
[394] König und Bömer, vid. op. cit. supra, S. 560.
[395] Vid. op. cit. supra, S. 562.
[396] Vid. op. cit. 53, p. 184.
[397] Vid. op. cit. 57, S. 374.
[398] Vid. op. cit. supra, S. 568.
[399] From συρφετος.
426. Introductory.—The importance of dairy products has led to the publication of a vast amount of literature relating thereto, and it seems almost a hopeless task to present even a typical abstract of the various analytical processes which have been proposed and used in their study. The general principles which have been developed in the preceding parts of this volume are applicable to the study of dairy products, and the analyst who is guided by them can intelligently examine the bodies specially considered in the present part. There have been developed, however, many valuable processes for the special examination of dairy products, which are of such a nature that they could not be properly discussed in the preceding pages. In the present part an effort will be made to present in a typical form the most important of these processes and to state the general principles on which they are based. This subject is naturally subdivided into three parts, viz., milk, butter and cheese. The milk sugar industry is not of sufficient importance to receive a special classification.
427. Composition of Milk.—The composition of milk not only varies with the genus and species of the mammal from which it is derived, but also depends in a marked degree on idiosyncrasy.[400]
Milk is a mixture containing water, proteids, fat, carbohydrates, organic and inorganic acids and mineral salts. There have also been observed in milk in minute quantities ammonia, urea, hypoxanthin, chyme, chyle, biliverdin, cholesterin, mucin, lecithin, kreatin, leucin and tyrosin. In the fermentation which milk undergoes in incipient decomposition there is sometimes developed from the proteid matter, as pointed out by Vaughn, a ptomaine, tyrotoxicon, which is a virulent poison.[401] The presence of these last named bodies is of interest chiefly to the physiologist and pathologist and can receive no further attention here. [Pg 465]
From a nutritive point of view, the important components of milk are the fats, proteids and sugar, but especially in the nourishment of the young the value of lime and phosphoric acid must be remembered. The mean composition of the most important milks, as determined by recent analyses, is given below:
| Water. Per cent. |
Sugar. Per cent. |
Proteids. Per cent. |
Fat. Per cent. |
Ash. Per cent. |
|
|---|---|---|---|---|---|
| Cow | 86.90 | 4.80 | 3.60 | 4.00 | 0.70 |
| Human | 88.75 | 6.00 | 1.50 | 3.45 | 0.30 |
| Goat | 85.70 | 4.45 | 4.30 | 4.75 | 0.80 |
| Ass | 89.50 | 6.25 | 2.00 | 1.75 | 0.50 |
| Mare | 90.75 | 5.70 | 2.00 | 1.20 | 0.35 |
| Sheep | 80.80 | 4.90 | 6.55 | 6.85 | 0.90 |
The mean composition of milk, as given by Watts and König, is given in the following tables:
| Watts. | ||||||
|---|---|---|---|---|---|---|
| Water. | Solids. | Proteids. | Fats. | Sugar. | Mineral Salts. |
|
| Woman | 87.65 | 12.35 | 3.07 | 3.91 | 5.01 | 0.17 |
| Ass | 90.70 | 9.30 | 1.70 | 1.55 | 5.80 | 0.50 |
| Cow | 86.56 | 13.44 | 4.08 | 4.03 | 4.60 | 0.73 |
| Goat | 86.76 | 13.24 | 4.23 | 4.48 | 3.91 | 0.62 |
| Sheep | 83.31 | 16.69 | 5.73 | 6.05 | 3.96 | 0.68 |
| Mare | 82.84 | 17.16 | 1.64 | 6.87 | 8.65 | |
| König. | |||||
|---|---|---|---|---|---|
| Water. | Fat. | Casein and albumin. |
Milk Sugar. |
Ash. | |
| Woman | 87.41 | 3.78 | 2.29 | 6.21 | 0.31 |
| Mare | 90.78 | 1.21 | 1.99 | 5.67 | 0.35 |
| Ass | 89.64 | 1.63 | 2.22 | 5.99 | 0.51 |
| Cow | 87.17 | 3.69 | 3.55 | 4.88 | 0.71 |
The average composition of 120,540 samples of cow milk, as determined by analysis, extending over a period of eleven years, was found by Vieth to be as follows:[402]
| Per cent. | |
| Total solids | 12.9 |
| Solids not fat | 8.8 |
| Fat | 4.1 |
[Pg 466] The quantity of solids and fat in milk is less after longer than after shorter periods between milkings.
The quantity of solids and fat in cow milk is less in the spring than in the autumn.
The chief organic acid naturally present in milk is citric, which exists probably in combination with lime.
The mean content of citric acid in milk is about one-tenth of one per cent.[403]
Citric acid is not found in human milk, and probably exists only in the mammary secretions of herbivores.
Among the mineral acids of milk, phosphoric is the most important, but a part of the phosphorus found as phosphoric acid in the ash of milk may come from pre-existing organic phosphorus (lecithin, nuclein).
The sulfuric acid, which is found in the ash of milk, is derived from the sulfur of the proteid matter during ignition.
Lactic acid is developed from lactose during the souring of milk as the result of bacterial activity.
Gases are also found in solutions of milk, notably carbon dioxid, which gives to freshly drawn milk its brothy appearance.
The ash of milk has the following composition expressed as grams per liter of the original milk:[404]
| Component. | Grams per liter. |
Probable form of combination. |
Grams per liter. |
|---|---|---|---|
| Chlorin | 0.90 | sodium chlorid | 0.962 |
| potassium chlorid | 0.830 | ||
| Phosphoric acid | 2.42 | KH₂PO₄ | 1.156 |
| K₂HPO₄ | 0.853 | ||
| MgHPO₄ | 0.336 | ||
| CaHPO₄ | 0.671 | ||
| Ca₃(PO₄)₂ | 0.806 | ||
| Potassium | 1.80 | (as shown above) | |
| and as potassium citrate | 0.495 | ||
| Sodium | 0.49 | sodium chlorid | 0.962 |
| Lime | 1.90 | (as shown above) | |
| and as calcium citrate | 2.133 | ||
| Magnesia | 0.20 | MgHPO₄ | 0.336 |
The percentage composition of the ash of milk, according to Fleischmann [Pg 467] and Schrott, is expressed as follows:[405]
| Per cent. | ||
| Potassium oxid, | K₂O | 25.42 |
| Sodium oxid, | Na₂O | 10.94 |
| Calcium oxid, | CaO | 21.45 |
| Magnesium oxid, | MgO | 2.54 |
| Iron oxid, | Fe₂O₃ | 0.11 |
| Sulfuric acid, | SO₃ | 4.11 |
| Phosphoric acid, | P₂O₅ | 24.11 |
| Chlorin, | Cl | 14.60 |
| 103.28 | ||
| Less | Cl as O | 3.28 |
| 100.00 | ||
428. Alterability of Milk.—The natural souring and coagulation of milk is attributed by most authorities to bacterial action produced by infection from the air or containing vessels.[406] Pasteur, however, shows that fresh milk sterilized at a temperature of 110° may be exposed to the air without danger of souring.[407] After about three days, however, a fermentation is set up which is totally different from that produced by the microzymes naturally present in the milk. This point has been further investigated by Béchamp, who finds that the natural souring of milk is accomplished without the evolution of any gas, while the fermentation produced in sterilized milk by the microbes of the air, is uniformly attended by a gaseous development.[408] As a result of his investigations, he concludes that the souring of milk takes place spontaneously by reason of milk being an organic matter, in the physiological sense of the term, and that this alteration is produced solely by the natural microzymes of the milk.
According to Béchamp, the milk derived from healthy animals is capable of spontaneous alteration, which consists in the development of lactic acid and alcohol, and of curd in those milks which contain caseinates produced by the precipitating action of the acids formed. Oxygen and the germs which are present in the air, according to him, have nothing to do with this alteration in the properties of milk. Milk belongs to that class of organic bodies like blood, which are called organic from a physiological point of view, on account of containing automatic forces [Pg 468] which produce rapid changes therein when they are withdrawn from the living organisms.
After milk has become sour by the spontaneous action of the microzymes which it contains, there are developed micro-organisms, such as vibriones and bacteria from a natural evolution from the microzymes.
Milk which is sterilized at a high temperature, viz., that of boiling water or above, is no longer milk in the true physiological sense of that term. The globules of the milk undergo changes and the microzymes a modification of their functions, so that in milk thus altered by heat, they are able to produce a coagulation without development of acidity. The microzymes thus modified, however, retain to a large extent their ability to become active. Human milk differs from cow milk in containing neither caseinates nor casein, but special proteid bodies, and also a galactozyme or galactozymase functionally very different from that which exists in cow milk. The extractive matter is also a special kind, consisting of milk globules and microzymes belonging particularly to it and containing three times less phosphate and mineral salts than cow milk. Boiling the milk of the cow or other animals does not render it similar to that of woman. There is no treatment, therefore, of any milk which renders it entirely suited to the nourishment of infants. The composition of the milk of the cow may be represented by three groups:
1. Organic elements in suspension; consisting chiefly of the globules of the milk, which are mostly composed of the fat, of an epidermoid membrane containing mineral matter of special soluble albumins and of microzymes containing also mineral matter.
2. Dissolved constituents; consisting of caseinates, lactalbuminates, galactozymase, holding phosphates in combination, lactose, extractive matter, organic phosphates of lime, acetates, urea and alcohol.
3. Mineral matters in solution; consisting of sodium and calcium chlorids, carbon dioxid and oxygen.[409]
It will be noticed from the above classification that Béchamp fails to mention citrate of lime. It is scarcely necessary to add to this brief [Pg 469] résumé of the theories of Béchamp that they are entirely at variance with the opinions held by nearly all his contemporaries.
429. Effects of Boiling on Milk.—On boiling, the albumin in milk is coagulated and on separating the proteid bodies by saturation with magnesium sulfate no albumin is found in the filtrate. The total casein precipitated from boiled is therefore greater than from unboiled milk. Jager has shown that the casein can be precipitated from boiled milk by rennet, but with greater difficulty than from unboiled.[410] According to this author in 3.75 per cent of proteid in milk there are found 3.15 per cent of casein, 0.35 of albumin and 0.25 of globulin.
430. Appearance of the Milk.—The color, taste, odor and other sensible characters of the milk are to be observed and noted at the time the sample is secured. Any variation from the faint yellow color of the milk is due to some abnormal state. A reddish tint indicates the admixture of blood, while a blue color is characteristic of the presence of unusual micro-organisms. Odor and taste will reveal often the character of the food which the animals have eaten. Any marked departure of the sample from the properties of normal milk should at once lead to its condemnation for culinary or dietetic purposes.
431. Micro-Organisms of the Milk.—Milk is a natural culture solution for the growth of micro-organisms, and they multiply therein with almost incredible rapidity. Some of these are useful, as, for instance, those which are active in the ripening of cream, and others are of an injurious nature, producing fermentations which destroy the sugars or proteids of the milk and develop acid, alcohol, mucous or ptomaine products. It is not possible here to even enumerate the kinds of micro-organisms which abound in milk and the reader is referred to the standard works on that subject.[411]
For analytical purposes it is important that the sample be kept as free as possible of all micro-organisms, good or bad, which may be accomplished by some of the methods given below.
432. Sampling Milk.—It is not difficult to secure for [Pg 470] examination representative samples of milk, if the proper precautions be taken. On the other hand, the ease and rapidity with which a milk undergoes profound changes render necessary a careful control of the methods of taking samples. The most rapid changes to which a mass of milk is obnoxious are due to the separation of the fat particles and to the action of bacteria. Even after standing for a few minutes, it will be found that the fat globules are not evenly distributed. Before securing the sample for analysis, it is necessary to well stir or mix the milk. A mean sample may also be secured from a can of milk by the sampling tube devised by Scovell, which will be described below.
In securing samples, a full detailed description of the cow or herd furnishing them is desirable, together with all other data which seem to illustrate in any way the general and particular conditions of the dairy. Samples are to be preserved in clean, well stoppered vessels, properly numbered and securely sealed.

Fig. 106.—Scovell’s Milk Sampling Tube.
433. Scovell’s Milk Sampler.—In sampling large quantities of milk in pails or shipping cans, it is exceedingly inconvenient to mix the milk by pouring from one vessel to another or by any easy process of stirring. In order to get representative samples in such conditions, Scovell has put in use a sampler, by means of which a typical portion of the milk may be withdrawn from a can without either pouring or stirring. The construction of the sampler is shown in Fig. 106, representing it in outline and longitudinal section. The tube a, made of brass, is open at both ends and of any convenient dimensions. Its lower end slides in a large tube b, closed at the bottom and having three elliptical, lateral openings c, which admit the milk as the tube is slowly depressed in the contents of the can. In [Pg 471] getting the sample, a is raised as shown in profile. When the bottom of b reaches the bottom of the can a is pushed down as shown in the section. The milk contained in the sampler is then readily withdrawn.
434. Preserving Milk for Analysis.—Pasteurizing or boiling the sample is not advisable by reason of the changes produced in the milk by heat. The milk sample may be preserved by adding to it a little chloroform, one part in 100 being sufficient. Boric and salicylic acids may also be used, but not so advantageously as formaldehyd or mercuric chlorid. Rideal has observed that one part of formaldehyd will preserve 10,000 parts of milk in a fresh state for seven days. The formaldehyd sold in the trade contains about one part of formaldehyd in 320 of the mixture. One-half pint of this commercial article is sufficient for about twenty gallons of milk, corresponding to about one part of pure formaldehyd to 45,000 parts of milk. Rideal much prefers formalin (formaldehyd) to borax or boric acid as a milk preservative. No ill effects due to its toxic action have been observed, even when it is consumed in a one per cent solution.[412]
Samples of milk can be kept in this way from four to six weeks by adding about one drop of the commercial formaldehyd to each ounce of sample. The analyst should remember in such cases that the formaldehyd may not all escape on evaporation, on account of forming some kind of a compound with the constituents of the milk, as is pointed out by Bevan.[413]
Bevan suggests that the formaldehyd may not actually be retained in the sample, but that the increase in the apparent amount of total solids is due to the conversion of the lactose into galactose. This point, however, has not been determined.
Richmond and Boseley propose to detect formalin by means of diphenylamin. A solution of diphenylamin is made with water, with the help of just enough sulfuric acid to secure a proper solvent effect. The liquid to be tested, which is supposed to contain formaldehyd, or the distillate therefrom, is added to this solution and boiled. If formaldehyd be present, a white flocculent precipitate is deposited, which is colored green if the acid used contain nitrates. For other methods of detecting formalin and for a partial literature of the subject the paper mentioned above may be consulted. [Pg 472]
One gram of fine-ground mercuric chlorid dissolved in 2,000 grams of milk will preserve it, practically unchanged, for several days. One gram of potassium bichromate dissolved in one liter of milk will also preserve it for some time. Thymol, hydrochloric acid, carbon disulfid, ether and other antiseptics may also be employed. No more of the preserving agent should be used than is required to keep the milk until the analysis is completed.
All methods of preservation are rendered more efficient by the maintenance of a low temperature, whereby the vitality of the bacteria is greatly reduced.
435. Freezing Point of Milk.—By reason of its content of sugar and other dissolved solids, the freezing point of milk is depressed below 0°. A good idea of the purity of whole milk is secured by subjecting it to a kryoscopic test. The apparatus employed for this purpose is that used in general analytical work in the determination of freezing points. Pure full milk freezes at about 0°.55 below zero, and any marked variation from this number shows adulteration or abnormal composition.[414] A simple apparatus, especially adapted to milk, is described by Beckmann.[415] The kryoscopic investigation may also be extended to butter fat dissolved in benzol.
436. Electric Conductivity of Milk.—The electric conductivity of milk may also be used as an index of its composition. The addition of water to milk diminishes its conductivity.[416] This method of investigation has at present but little practical value.
437. Viscosity Of Milk.—The viscosity of milk may be determined by the methods already described. Any variation from the usual degree of fluidity is indicated either by the abstraction of some of the contents of the milk, the addition of some adulterant or the result of fermentation.
438. Acidity and Alkalinity of Milk.—Fresh milk of normal constitution has an amphoteric reaction. It will redden blue and blue red litmus paper. This arises from the presence in the milk of both neutral and acid phosphates of the alkalies. A saturated alkaline phosphate, i. e., one in which all the acid hydrogen of the acid [Pg 473] has been replaced by the base has an alkaline reaction while the acid phosphates react acid. When fresh milk is boiled its reaction becomes strongly alkaline and this arises chiefly from the escape of the dissolved carbon dioxid. By the action of micro-organisms on the lactose of milk, the alkaline reaction soon becomes acid, and delicate test paper will show this decomposition long before it becomes perceptible to the taste. It is advisable to test the reactions of the milk as soon as possible after it is drawn from the udder, both before and after boiling.
439. Determination of the Acidity of Milk.—In the determination of the acidity of milk it is important that it first be freed of the carbon dioxid it contains.[417] Van Slyke has found that too high results are obtained by the direct titration of milk for acidity, and when the milk is previously diluted the results are also somewhat too high.[418] Good results are got by diluting the milk with hot water and boiling for a short time to expel the carbon dioxid. Twenty-five cubic centimeters of milk are diluted with water to about a quarter of a liter, as above, two cubic centimeters of a one per cent alcoholic phenolphthalien added and the titration accomplished by decinormal alkali. This variation of the methods of procedure, suggested by Hopkins and Powers, appears to be the best process at present known for the determination of acidity. The reader is referred to the paper cited above for references to other methods which have been proposed.
440. Opacity Of Milk.—The white color and opacity of milk are doubtless due to the presence of the suspended fat particles and to the colloid casein. On the latter it is probably principally dependent since the color of milk is not very sensibly changed after it has passed the extractor, which leaves not to exceed one-tenth of one per cent of fat in it. Some idea of the quality of the milk, however, may be obtained by determining its opacity. This is accomplished by the use of a lactoscope. The one generally employed was devised by Feser and is shown in Fig. 107.
The instrument consists of a cylindrical glass vessel of a little more [Pg 474] than 100 cubic centimeters content, in the lower part of which is set a cone of white glass marked with black lines. Into this part are placed four cubic centimeters of milk. A small quantity of water is added and the contents of the vessel shaken. This operation is repeated until the black lines on the white glass just become visible. The graduations on the left side show the volume of water which is necessary to bring the dark lines into view, while those on the right indicate approximately the percentage of fat present.
Among the other lactoscopes which have been used may be mentioned those of Donné, Vogel, Hoppe-Seyler, Trommer, Seidlitz, Reischauer, Mittelstrass, Hénocque, and Heusner.[419] Since the invention of so many quick and accurate methods of fat estimation these instruments have little more than a historical interest.

Fig. 107.—Lactoscope, Lactometer and Creamometer.
441. Creamometry.—The volume of cream which a sample of milk affords under arbitrary conditions of time and temperature is sometimes of value in judging the quality of milk. A convenient creamometer is a small cylinder graduated in such a way that the volume of cream separated in a given time can be easily noted. There are many kinds of apparatus used for this purpose, a typical one being shown in Fig. 107.
The usual time of setting is twenty-four hours. A quicker determination is secured by placing the milk in strong glass graduated tubes and subjecting these to centrifugal action. The process is not exact and is now rarely practiced as an analytical method, even for valuing the butter making properties of milk.
442. Specific Gravity.—The specific gravity of milk is uniformly referred to a temperature of 15°. Generally no attempt is made [Pg 475] to free the milk of dissolved gases beforehand. This should not be done by boiling but by placing the sample in a vacuum for some time. Any of the methods described for determining specific gravity in sugar solutions may be used for milk (48-59). The specific gravity of milk varies in general from 1.028 to 1.034. Nearly all good cow milk from herds will show a specific gravity varying from 1.030 to 1.032. In extreme cases from single cows the limits may exceed those first given above, but such milk cannot be regarded as normal.
Increasing quantities of solids not fat in solution, tend to increase the specific gravity, while an excess of fat tends to diminish it. There is a general ratio existing between the solids not fat and the fat in cow milk, which may be expressed as 9: 4. The removal of cream and the addition of water in such a manner as not to affect the specific gravity of the sample disturbs this ratio.
The determination of the specific gravity alone, therefore, cannot be relied upon as an index of the purity of a milk.
443. Lactometry.—A hydrometer especially constructed for use in determining the density of milk is called a lactometer. In this country the one most commonly used is known as the lactometer of the New York Board of Health. It is a hydrometer, delicately constructed, with a large cylindrical air space and a small stem carrying the thermometric and lactometric scales. It is shown held in the creamometer in Fig. 107. The milk is brought to a temperature of 60° F. and the reading of the lactometer scale observed. This is converted into a number expressing the specific gravity by means of a table of corresponding values given below. Each mark on the scale of the instrument corresponds to two degrees and these marks extend from 0° to 120°. The numbers of this scale can be converted into those corresponding to the direct reading instrument, described in the next paragraph, by multiplying them by 0.29.
The minimum density for whole milk at 60° F. is fixed by this instrument at 100°, corresponding to a specific gravity of 1.029. The instrument is also constructed without the thermometric scale. The mean [Pg 476] density of many thousand samples of pure milk, as observed by the New York authorities, is 1.0319.
The specific gravity is easily secured, and while not of itself decisive, should always be determined. The specific gravity of milk increases for some time after it is drawn and should be made both when fresh and after the lapse of several hours.[420]
Table Showing Specific Gravities Corresponding
to Degrees of the New York Board Of Health
Lactometer. Temperature 60° F.
| Degree. | Sp. gr. | Degree. | Sp. gr. |
|---|---|---|---|
| 90 | 1.02619 | 106 | 1.03074 |
| 91 | 1.02639 | 107 | 1.03103 |
| 92 | 1.02668 | 108 | 1.03132 |
| 93 | 1.02697 | 109 | 1.03161 |
| 94 | 1.02726 | 110 | 1.03190 |
| 95 | 1.02755 | 111 | 1.03219 |
| 96 | 1.02784 | 112 | 1.03248 |
| 97 | 1.02813 | 113 | 1.03277 |
| 98 | 1.02842 | 114 | 1.03306 |
| 99 | 1.02871 | 115 | 1.03335 |
| 100 | 1.02900 | 116 | 1.03364 |
| 101 | 1.02929 | 117 | 1.03393 |
| 102 | 1.02958 | 118 | 1.03422 |
| 103 | 1.02987 | 119 | 1.03451 |
| 104 | 1.03016 | 120 | 1.03480 |
| 105 | 1.03045 |
444. Direct Reading Lactometer.—A more convenient form of lactometer is one which gives the specific gravity directly on the scale. The figures given represent those found in the second and third decimal places of the number expressing the specific gravity. Thus 31 on the scale indicates a specific gravity of 1.031. This instrument is also known as the lactometer of Quévenne. For use with milk, the scale of the instrument does not need to embrace a wider limit than from 25 to 35, and such an instrument is capable of giving more delicate readings than when the scale extends from 14 to 42, as is usually the case with the quévenne instrument.
Langlet has invented a lactoscope with a scale, showing the corrections to be applied for temperatures other than 15°. A detailed description of this instrument, as well as the one proposed by Pinchon, is unnecessary.[421]
[Pg 477] 445. Density of Sour Milk.—Coagulated milk cannot be used directly for the determination of the specific gravity, both because of its consistence and by reason of the fact that the fat is more or less completely separated. In such a case, the casein may be dissolved by the addition of a measured quantity of a solvent of a known specific gravity, the density of the resulting solution determined and that of the original milk calculated from the observed data. Ammonia is a suitable solvent for this purpose.[422]
446. Density of the Milk Serum.—The specific gravity of the milk serum, after the removal of the fat and casein by precipitation and filtration, may also be determined. For normal cow milk the number is about 1.027.
447. Total Solids.—The direct gravimetric determination of the total solids in milk is attended with many difficulties, and has been the theme of a very extended periodical literature. A mere examination of the many processes which have been proposed would require several pages.
The most direct method of procedure is to dry a small quantity of milk in a flat-bottom dish to constant weight on a steam-bath. The surface of the dish should be very large, even for one or two grams of milk; in fact the relation between the quantity of milk and the surface of the dish should be such that the fluid is just sufficient in amount to moisten the bottom of the dish with the thinnest possible film. The dish, during drying, is kept in a horizontal position at least until its contents will not flow. The water of the sample will be practically all evaporated in about two hours. The operation may be accelerated by drying in vacuo.
The drying may also be accomplished by using a flat-bottom dish containing some absorbent, such as sand, pumice stone, asbestos or crysolite. The milk may also be absorbed by a dried paper coil and dried thereon (26).
It is convenient to determine the water in the sample subsequently to be used for the gravimetric determination of the fat, and this is secured by the adoption of the paper coil method, as suggested by the author, or by the use of a perforated metal tube containing porous asbestos, as proposed by Babcock.[423]
[Pg 478] The process is conveniently carried out as follows:
Provide a hollow cylinder of perforated sheet metal sixty millimeters long and twenty millimeters in diameter, closed five millimeters from one end by a disk of the same material. The perforations should be about 0.7 millimeter in diameter and as close together as possible. Fill loosely with from one and a half to two and a half grams of dry woolly asbestos and weigh. Introduce a weighed quantity of milk (about five grams). Dry at 100° for four hours. During the first part of the drying the door of the oven should be left partly open to allow escape of moisture. Cool in a desiccator and weigh. Repeat the drying until the weight remains constant. Place in an extractor and treat with anhydrous ether for two hours. Evaporate the ether and dry the fat at 100°. The extracted fat is weighed and the number thus obtained may be checked by drying and weighing the cylinder containing the residue.
The asbestos best suited for use in this process should be of a woolly nature, quite absorbent, and, previous to use, be ignited to free it of moisture and organic matter. A variety of serpentine, crysolite is sometimes used instead of asbestos. When the content of water alone is desired, it is accurately determined by drying in vacuo over pumice stone (page 33).
The methods above mentioned are typical and will prove a sufficient guide for conducting the desiccation, either as described or by any modification of the methods which may be preferred.
448. Calculation of Total Solids.—By reason of the ease and celerity with which the density of a milk and its content of fat can be obtained, analysts have found it convenient to calculate the percentage of total solids instead of determining it directly. This is accomplished by arbitrary formulas based on the data of numerous analyses. These formulas give satisfactory results when the samples do not vary widely from the normal and may be used with advantage in most cases.
Among the earliest formulas for the calculation may be mentioned those of Fleischmann and Morgen,[424] Behrend and Morgen,[425] Claus, Stutzer and Meyer,[426] Hehner,[427] and Hehner and Richmond.[428] Without doing more than citing these papers it will be sufficient here [Pg 479] to give the formulas as corrected by the most recent experience.
In the formula worked out by Babcock the specific gravity of the sample is represented by S, the fat by F, and the solids not fat by t. The formula is written as follows:[429]
| t = ( | 100S - FS | ) (250 - 2.5 F). |
| 100 - 1.0753FS |
In this formula it is assumed that the difference between the specific gravity of the milk serum and that of water is directly proportional to the per cent of solids in the serum, but this assumption is not strictly correct. Even in extreme cases, however, the error does not amount to more than 0.05 per cent.
Since a given amount of milk sugar increases the density of a milk more than the same quantity of casein, it is evident that the formula would not apply to those instances in which the ratio between these two ingredients is greatly disturbed, as for instance, the whey.
The formula of Hehner and Richmond, in its latest form, is expressed as follows:
| T = 0.2625 | G | + 1.2F, |
| D |
in which T represents the total solids, G the reading of the quévenne lactometer, D the specific gravity, and F the fat.
Example.—Let the reading of the lactometer be 31, corresponding to D 1.031, and the percentage of fat be three and five-tenths, what is the percentage of the total solids?
Substituting these values in the formulas we have
| T = 0.2625 | 31 | + 1.2 × 3.5 = 12.09. |
| 1.031 |
To simplify the calculations, Richmond’s formula may be written
| T = | G | + | 6F | + 0.14. |
| 4 | 5 |
Calculated by this shortened formula from the above data T = 12.09, the same as given in the larger formula.
Calculating the solids not fat in the hypothetical case given above by Babcock’s formula, we get t = 8.46, and this plus 3.5 gives 11.96, which is slightly lower than the number obtained by the richmond process. [Pg 480]
The babcock formula may be simplified by substituting the number expressing the reading of the quévenne lactometer for that donating the specific gravity, in other words, the specific gravity multiplied by 100 and the quotient diminished by 1000.
The formulas for solids not fat and total solids then become
| t = | L | + 0.2F, and T = | L | + 1.2F, |
| 4 | 4 |
in which L represents the reading of the lactometer. By the addition of the constant factor 0.14 the results calculated by the formula of Babcock are the same as those obtained by the method of Richmond.
In the following table are given the solids not fat in milks as calculated by Babcock’s formula. To obtain the total solids add the per cent of fat to solids not fat. To obtain total solids according to Richmond’s formula increase that number by 0.14.
Table Showing Per Cent of Solids not Fat in Milk
Corresponding to Quévenne’s Lactometer Readings
and Per Cent of Fat.
[Pg 482] 449. Determination of Ash.—In the determination of the solid residue obtained by drying milk, it is important to observe the directions already given (28-32).
In the direct ignition of the sample, a portion of the sulfur and phosphorus may escape oxidation and be lost as volatile compounds. This loss may be avoided by the use of proper oxidizing agents or by conducting the combustion as heretofore described.[430] In the official method, it is directed to add six cubic centimeters of nitric acid to twenty of milk, evaporate to dryness and ignite the residue at a low red heat until free of carbon.[431] It is doubtful if this precaution be entirely sufficient to save all the sulfur and phosphorus, but the method is evidently more reliable than the common one of direct ignition without any oxidizing reagent whatever.
450. Form of Fat in Milk.—The fat in milk occurs in the form of globules suspended in the liquid, in other words in the form of an emulsion. Many authorities have asserted that each globule of fat is contained in a haptogenic membrane composed presumably of nitrogenous matter, but there is no convincing evidence of the truth of this opinion. The weight of experimental evidence is in the opposite direction. The supposed action of the membrane and the phenomena produced thereby are more easily explained by the surface tension existing between the fat globules and the menstruum in which they are suspended.
Babcock affirms that the spontaneous coagulation of the fibrin present in milk tends to draw the fat globules into clusters, and this tendency can be arrested by adding a little soda or potash lye to the milk as soon as it is drawn.[432]
The diameter of the fat globules is extremely variable, extending in some cases from two to twenty micromillimeters. In cow milk, the usual diameters are from three to five micromillimeters.
451. Number of Fat Globules in Milk.—The number of fat globules [Pg 483] in milk depends on their size and the percentage of fat. It is evident that no definite statement of the number can be made. There is a tendency, on the part of the globules, to diminish in size and increase in number as the period of lactation is prolonged. To avoid large numbers, it is convenient to give the number of globules in 0.0001 cubic millimeter. This number may be found within wide limits depending on the individual, race, food and other local conditions to which the animal or herd is subjected. In general, in whole milk this number will be found between 140 and 250.
452. Method of Counting Globules.—The number of globules in milk is computed with the aid of the microscope. The most convenient method is the one devised by Babcock.[433] In carrying out this computation, capillary tubes, from two to three centimeters long and about one-tenth millimeter in internal diameter, are provided. The exact diameter of each tube, in at least three points, is determined by the micrometer attachment of the microscope, and from these measurements the mean diameter of the tube is calculated. This known, its cubic content for any given length is easily computed. Ten cubic centimeters of the milk are diluted with distilled water to half a liter and one end of a capillary tube dipped therein. The tube is quickly filled with diluted milk and each end is closed with a little wax to prevent evaporation. Several of these tubes being thus prepared, they are placed in a horizontal position on the stage of the microscope and covered with glycerol and a cover glass. The tubes are left at rest for some time until all the fat globules have attached themselves to the upper surfaces, in which position they are easily counted. The micrometer is so placed as to lie parallel with the tubes, and the number of globules, corresponding to each division of its scale, counted. The mean number of globules corresponding to each division of the micrometer scale is thus determined.
To compare the data obtained with each tube they are reduced to a common basis of the number of globules found in a length of fifty divisions of the micrometer scale in a tube having a diameter of 100 divisions, using the formula
| N = | 10000n |
| d² |
[Pg 484] in which n = the number of globules found in the standard length of tube measured and d = the diameter of the tube. It is not difficult to actually count all the globules in a length of fifty divisions of the scale, but the computation may also be made from the mean numbers found in a few divisions. The usual number of globules found in a length of 0.1 millimeter in a tube 0.1 millimeter in diameter, varies from fifty to one hundred.
Example.—The length of one division of the micrometer scale is 0.002 millimeter, and the internal diameter of the tube 0.1 millimeter. The content of a tube, of a length of 0.002 × 50 = 0.1 millimeter, is therefore 0.0007854 cubic millimeter.
The cubic content of a tube 100 scale divisions in diameter and fifty in length is 0.0031416 cubic millimeter. The number of globules found in fifty divisions of the tubes used is 40. Then the number which would be contained in a tube of a diameter of 100 divisions of the micrometer scale and a length of fifty divisions thereof is
| N = | 10000n | = | 400000 | = 160. |
| d² | 2500 |
Since the milk is diluted fifty times, the actual number of globules corresponding to the volume given is 8000. It is convenient to reduce the observations to some definite volume, exempla gratia, 0.0001 cubic centimeter. The equation for this in the above instance is 0.0031416: 0.0001 = 8000: x, whence x = 223, = number of fat globules in 0.0001 cubic millimeter.
In one cubic millimeter of milk there are therefore 2,230,000 fat globules, and in one cubic centimeter 2,230,000,000 globules. In a single drop of milk there are from one to two hundred million fat globules.[434]
453. Classification of Methods of Determining Fat in Milk.—The fat, being the most valuable of the constituents of milk, is the subject of a number of analytical processes. An effort will be made here to classify these various methods and to illustrate each class with one or more typical processes. In general the methods may be divided into analytical and commercial, those of the first class being used for scientific and of the other for trade purposes. For normal milk, some of the trade methods have proved to be quite as accurate as [Pg 485] the more chronokleptic analytical processes to which, in disputed cases, a final appeal must be taken. When the analyst is called upon to determine the fat in a large number of samples of milk some one of the trade methods may often be adopted with great advantage.
454. Dry Extraction Methods.—Among the oldest and most reliable methods of determining fat in milk, are included those processes based on the principle of drying the milk and extracting the fat from the residue by an appropriate solvent. The solvents generally employed are ether and petroleum spirit of low boiling point. The methods of drying are legion.
In extracting with ether, it must not be forgotten that other bodies than fat may pass into solution on the one hand and on the other any substituted glycerid, such as lecithin or nuclein, which may be present may escape solution, at least in part. Perhaps petroleum spirit, boiling at from 45° to 60°, is the best solvent for fat, but it is almost the universal custom in this and other countries to use ether.
455. The Official Methods.—In the methods adopted by the Association of Official Agricultural Chemists two processes are recommended.
(1) The Asbestos Process: In this process it is directed to extract the residue from the determination of water by the asbestos method (447) with anhydrous pure ether until the fat is removed, evaporate the ether, dry the fat at 100° and weigh. The fat may also be determined by difference, after drying the extracted cylinders at 100°.
(2) Paper Coil Method: This is essentially the method proposed by Adams as modified by the author.[435] Coils made of thick filter paper are cut into strips 6.25 by 62.5 centimeters, thoroughly extracted with ether and alcohol, or the weight of the extract corrected by a constant obtained for the paper. If this latter method be used, a small amount of anhydrous sodium carbonate should be added. Paper free of matters soluble in ether is also to be had for this purpose. From a weighing bottle about five grams of milk are transferred to the coil by a pipette, taking care to keep dry the [Pg 486] lower end of the coil. The coil, dry end down, is placed on a piece of glass, and dried at a temperature of boiling water for one hour, or better, dried in hydrogen at a temperature of boiling water, transferred to an extraction apparatus and extracted with absolute ether or petroleum spirit boiling at about 45°. The extracted fat is dried in hydrogen and weighed. Experience has shown that drying in hydrogen is not necessary. The fat may be conveniently dried in partial vacuo.
456. Variations of Extraction Method.—The method of preparing the milk for fat extraction is capable of many variations. Some of the most important follow:
(1) Evaporation on Sand: The sand should be pure, dry and of uniform size of grain. It may be held in a dish or tube. The dish may be made of tin foil, so that it can be introduced with its contents into the extraction apparatus after the desiccation is complete. For this purpose, it is cut into fragments of convenient size after its contents have been poured into the extractor. The scissors used are washed with the solvent.
(2) Evaporation on Kieselguhr: Dry kieselguhr (infusorial earth, tripoli) may take the place of the sand as above noted. The manipulation is the same as with sand.
(3) Evaporation on Plaster of Paris,[436] (Soxhlet Method),[437] (4) On Pumice Stone, (5) On Powdered Glass, (6) On Chrysolite:[438] The manipulation in these cases is conducted as with sand and no detailed description is required.
(7) Evaporation on Organic Substances: These variations would fall under the general heading of drying on paper. The following materials have been used; viz., sponge,[439] lint,[440] and wood pulp.[441] In these variations the principal precautions to be observed are to secure the organic material in a dry state and free of any matter soluble in the solvent used.
(8) Dehydration with Anhydrous Copper Sulfate: In this process the water of the sample is absorbed by powdered anhydrous copper sulfate, the residual mass extracted and the butter fat obtained determined by saponification and titration.[442] In the manipulation about twenty grams of the anhydrous copper sulfate [Pg 487] are placed in a mortar, a depression made therein in such a manner that ten cubic centimeters of milk can be poured into it without wetting it through to the mortar. The water is soon absorbed when the mass is ground with a little dry sand and transferred to the extractor.
Petroleum spirit of low boiling point is used as a solvent, successive portions of about fifteen cubic centimeters each being forced through the powdered mass under pressure. Two or three treatments with the petroleum are required. The residual butter fat, after the evaporation of the petroleum, is saponified with a measured portion, about twenty-five cubic centimeters, of seminormal alcoholic potash lye. The residual alkali is determined by titration with seminormal hydrochloric acid in the usual manner. From the data obtained is calculated the quantity of alkali employed in the saponification. The weight of butter fat extracted is then calculated on the assumption that 230 milligrams of potash are required to saponify one gram of the fat.
457. Gypsum Method for Sour Milk.—In sour milk, extraction of the dry residue with ether is attended with danger of securing a part of the free lactic acid in the extract. This may be avoided, at least in part, by making the milk neutral or slightly alkaline before desiccation. This method is illustrated by a variation of Soxhlet’s method of drying on gypsum proposed by Kühn.[443] The curdled milk is treated with potash lye of forty per cent strength until the reaction is slightly alkaline. For absorbing the sample before drying, a mixture is employed consisting of twenty-five grams of plaster of paris, four of precipitated carbonate of lime and two of acid potassium sulfate. To this mixture ten grams of the milk, rendered alkaline as above noted, are added in a desiccating dish, the excess of moisture evaporated at 100°, the residual mass finely ground and extracted with ether for four hours. A little gypsum may be found in the solution, but in such small quantities as not to interfere seriously with the accuracy of the results obtained.
458. Estimation of Fat in Altered Milk.—In altered milk the lactose has usually undergone a fermentation affording considerable quantities of lactic acid. If such milks be treated by the extraction method for fat, the results will always be too high, because of the solubility of lactic acid in ether. [Pg 488]
Vizern[444] has proposed to avoid this error by first warming the soured milk for a few minutes to 40°, at which temperature the clabber is easily divided by vigorous shaking. Of the milk thus prepared, thirty grams are diluted with two or three volumes of water and poured onto a smooth and moistened filter. The vessel and filter are washed several times until the filtrate presents no further acid reaction. The filter and its contents are next placed in a vessel containing some fine washed sand. A small quantity of water is added, sufficient to form a paste. With a stirring rod, the filter is entirely broken up and the whole mass thoroughly mixed. Dried on the water bath the material is subjected to extraction in the ordinary way. Several analyses made on fresh milk and on milk kept for several months show that almost identical results are obtained.
In respect of this process there would be danger, on long standing, of the formation of free acids from butter glycerids, and these acids would be removed by the process of washing prescribed. In this case the quantity of fat obtained would be less than in the original sample.
459. Comparison of Methods.—An immense amount of work has been done by analysts in comparing the various types of extraction methods outlined above.[445]
The consensus of opinion is that good results are obtained by all the methods when properly conducted, and preference is given to the two methods finally adopted by the Association of Official Chemists. As solvents, pure ether and petroleum spirit of low boiling point are preferred. The direct extraction gravimetric processes are important, since it is to these that all the other quicker and easier methods must appeal for the proof of their accuracy.
460. Wet Extraction Methods.—It has been found quite impracticable to extract the fat from milk by shaking it directly with the solvent. An emulsion is produced whereby the solvent itself becomes incorporated with the other constituents of the milk, and from which it is not separated easily even with the aid of whirling. The disturbing element which prevents the separation of the solvent is doubtless the [Pg 489] colloid casein, since, when this is previously rendered soluble, the separation of the solvent holding the fat is easily accomplished.
The principle on which the methods of wet extraction are based is a simple one; viz., to secure a complete or partial solution of the casein and subsequently to extract the fat with a solvent immiscible with water. The methods may be divided into three great classes; viz., (1) those in which the solvent is evaporated from the whole of the extracted fat and the residual matters weighed; (2) processes in which an aliquot part of the fat solution is employed and the total fat calculated from the data secured; (3) the density of the fat solution is determined at a definite temperature and the percentage of fat corresponding thereto determined from tables or otherwise. Methods (1) and (2) are practically identical in principle and one or the other may be applied according to convenience or to local considerations. The methods may be further subdivided in respect of the reagents used to secure complete or partial solution of the casein, as, for instance, alkali or acid.[446]
461. Solution in an Acid.—A good type of these processes is the method of Schmid.[447] In this process ten cubic centimeters of milk are placed in a test tube of about five times that content, graduated to measure small volumes. An equal quantity of hydrochloric acid is added, the mixture shaken, boiled until it turns dark brown, and cooled quickly. The fat is extracted by shaking with thirty cubic centimeters of ether. After standing some time the ethereal solution separates and its volume is noted. An aliquot part of the solution is removed, the solvent evaporated, and the weight of fat in the whole determined by calculation.
The schmid process has been improved by Stokes,[448] Hill,[449] and Richmond.[450] The most important of these variations consists in weighing instead of measuring the milk employed, thus insuring greater accuracy. Dyer and Roberts affirm that the ether dissolves some of the caramel products formed on boiling condensed milk with hydrochloric acid, and that the data obtained in such cases by the process of Schmid are too high.[451]
Since lactic acid is also slightly soluble in ether, sour milk should not be extracted with that solvent. In these cases petroleum spirit, or [Pg 490] a mixture of petroleum and ether, as suggested by Pinette, may be used.[452] Another variation consists in extracting the fat with several portions of the solvent and evaporating all the extracts thus obtained to get the total fat. This method is perhaps the best of those in which the fat is extracted from the residual liquid after the decomposition of the casein by an acid, and may be recommended as both reliable and typical within the limitations mentioned above.
462. Solution in an Alkali.—The casein of milk is not so readily dissolved in an alkali as in an acid, but the solution is sufficient to permit the extraction of the fat. Soda and potash lyes and ammonia are the alkaline bodies usually employed. To promote the separation of the emulsions, alcohol is added with advantage. The principle of the process rests on the observed power of an alkali to free the fat globules sufficiently to allow them to dissolve in ether or some other solvent. When the solvent has separated from the emulsion at first formed, the whole or a part of it is used for the determination of fat in a manner entirely analogous to that employed in the process with the acid solutions described above. There are many methods based on this principle, and some of the typical ones will be given below. Experience has shown that extraction from an alkaline solution is more troublesome and less perfect than from an acid and these alkaline methods are, therefore, not so much practiced now as they were formerly.
463. Method of Short.—Instead of measuring the volume of the separated fat, Short has proposed a method in which the casein is dissolved in an alkali and the fat at the same time saponified. The soap thus produced is decomposed by sulfuric acid and the volume of the separated fat acids noted. This volume represents eighty-seven per cent of the corresponding volume of fat.[453]
The solvent employed is a mixture of sodium and potassium hydroxids, containing in one liter 125 and 150 grams, respectively, of these alkalies. The sample of milk is mixed with half its volume of the reagent and placed in boiling water for two hours. By this treatment [Pg 491] the casein is dissolved and the fat saponified. After cooling to about 60°, the soap is decomposed by the addition of equal parts of sulfuric and acetic acids. The tubes containing the mixture are again placed in boiling water for an hour and they are then filled with boiling water to within one inch of the top. The tubes may either be furnished with a graduation or the column of fat be measured by a scale.
464. Method of Thörner.—The process of Short is conducted by Thörner as follows:[454]
Ten cubic centimeters of milk measured at 15° are saponified, in tubes fitting a centrifugal, by the addition of one and a half cubic centimeters of an alcoholic potash lye, containing 160 grams of potassium hydroxid per liter, or one cubic centimeter of an aqueous fifty per cent soda lye. The saponification is hastened by setting the tubes in boiling water, where they remain for two minutes. The soap formed is decomposed with a strong acid, sulfuric preferred, the tubes placed in the centrifugal and whirled for four minutes, when the fat acids will be formed in the narrow graduated part of the tube and the volume occupied thereby is noted after immersion in boiling water. Thörner’s process is not followed in this country, but is used to a considerable extent in Germany.[455]
465. Liebermann’s Method.—In this method, fifty cubic centimeters of milk, at ordinary temperatures, are placed in a glass cylinder twenty-five centimeters high and about four and a half internal diameter; five cubic centimeters of potash lye of 1.27 specific gravity are added, the cylinder closed with a well fitting cork stopper and thoroughly shaken.[456] After shaking, fifty cubic centimeters of petroleum spirit, boiling point about 60°, are added. The cylinder is again stoppered and vigorously shaken until an emulsion is formed. To this emulsion fifty cubic centimeters of alcohol of ninety-five per cent strength are added, and the whole again thoroughly shaken. After four or five minutes the petroleum spirit, containing the fat, separates. In order to insure an absolute separation of the fat, however, the shaking may be repeated three or four times for about one-quarter minute, waiting each time between the shakings until the spirit separates. [Pg 492]
Of the separated petroleum spirit twenty cubic centimeters are placed in a small weighed flask. The use of the flask is recommended on account of the ease with which the petroleum spirit can be evaporated without danger of loss of fat. Instead of the flask a weighed beaker or other weighed dish may be employed.
The petroleum spirit is carefully evaporated on a water-bath and the residue dried at 110° to 120° for one hour. The weight found multiplied by five gives the content of fat in 100 cubic centimeters of the milk. The percentage by weight can then be calculated by taking into consideration the specific gravity of the milk employed.
The results obtained by this method agree well with those obtained by the paper coil method, when petroleum spirit instead of sulfuric ether is used as the solvent for the fat. Sulfuric ether, however, gives an apparently higher content of fat because of the solution of other bodies not fat present in the milk.
466. Densimetric Methods.—Instead of evaporating the separated fat solution and weighing the residue, its density may be determined and the percentage of fat dissolved therein obtained by calculation, or more conveniently from tables. The typical method of this kind is due to Soxhlet, and until the introduction of modern rapid volumetric processes, it was used perhaps more extensively than any other proceeding for the determination of fat in milk.[457] The reagents employed in the process are ether saturated with water and a potash lye containing 400 grams of potash in a liter. The principle of the process is based on the assumption that a milk made alkaline with potash will give up all its fat when shaken with ether and the quantity of fat in solution can be determined by ascertaining the specific gravity of the ethereal solution. [Pg 493]

Fig. 108. Areometric Fat Apparatus.
[Pg 494] The apparatus is arranged as shown in Fig. 108, whereby it is easy to drive the ethereal fat solution into the measuring vessel by means of the bellows shown. In the bottle, seen at the right of the engraving are placed 200 cubic centimeters of milk, ten of the potash lye and sixty of the aqueous ether. The milk and potash are first added and well shaken, the ether then added, and the contents of the bottle are shaken until a homogeneous emulsion is formed. The bottle is then set aside for the separation of the ethereal solution, which is promoted by gently jarring it from time to time. When the chief part of the solution has separated, a sufficient quantity of it is driven over into the measuring apparatus, by means of the air bulbs, to float the hydrometer contained in the inner cylinder. After a few moments the scale of the oleometer is read and the percentage of fat calculated from the table. All the measurements are made at a temperature of 17°.5. The temperature is preserved constant by filling the outer cylinder of the apparatus with water. If the room be warmer than 17°.5, the water added should be at a temperature slightly below that and vice versa. The oleometer carries a thermometer which indicates the moment when the reading is to be made.
The scale of the oleometer is graduated arbitrarily from 43 to 66, corresponding to the specific gravities 0.743 and 0.766, respectively, or to corresponding fat contents of 2.07 and 5.12 per cent, in the milk, a range which covers most normal milks.
In the use of the table the per cents corresponding to parts of an oleometer division can be easily calculated.
Table for Calculating
Per Cent of Fat in Milk
by Areometric Method of Soxhlet.
| Reading of oleometer. |
Per cent fat in milk. |
Reading of oleometer. |
Per cent fat in milk. |
|---|---|---|---|
| 43 | 2.07 | 55 | 3.49 |
| 44 | 2.18 | 56 | 3.63 |
| 45 | 2.30 | 57 | 3.75 |
| 46 | 2.40 | 58 | 3.90 |
| 47 | 2.52 | 59 | 4.03 |
| 48 | 2.64 | 60 | 4.18 |
| 49 | 2.76 | 61 | 4.32 |
| 50 | 2.88 | 62 | 4.47 |
| 51 | 3.00 | 63 | 4.63 |
| 52 | 3.12 | 64 | 4.79 |
| 53 | 3.25 | 65 | 4.95 |
| 54 | 3.37 | 66 | 5.12 |
467. Application of the Areometric Method.—Soxhlet’s method, as outlined above, with many modifications, has been extensively used in [Pg 495] Europe and to a limited degree in this country, and the results obtained are in general satisfactory, when the sample is a mixed one from a large number of cows and of average composition.
The author has shown that the process is not applicable to abnormal milk and often not to milk derived from one animal alone.[458]
The chief difficulty is found in securing a separation of the emulsion. This trouble can usually be readily overcome by whirling. Any centrifugal machine, which can receive the bottle in which the emulsion is made, may be employed for that purpose.
Since the introduction of more modern and convenient methods of fat determination, the areometric method has fallen into disuse and perhaps is no longer practiced in this country. It is valuable now chiefly from the fact that many of the recorded analyses of milk fat were made by it, and also for its typical character in representing all methods of analysis of fat in milk based on the density of ethereal solutions.
468. The Lactobutyrometer.—A typical instrument for measuring the volume of fat in a milk is known as Marchand’s lactobutyrometer. It is based on the observation that ether will dissolve the fat from milk when the casein is wholly or partly dissolved by an alkali, and further, that the fat in an impure form can be separated from its ethereal solution by the action of alcohol. Experience has shown that all the fat is not separated from the ethereal solution by this process, and also that the part separated is a saturated solution in ether. The method cannot be rigorously placed in the two classes given above, but being volumetric demands consideration here chiefly because of its historical interest.[459]
The instrument employed by Marchand is a tube about thirty centimeters long and twelve in diameter, closed at one end and marked in three portions of ten cubic centimeters each. The upper part is divided in tenths of a cubic centimeter. The superior divisions are subdivided so that the readings can be made to hundredths of a cubic centimeter.
The tube is filled with milk to the first mark and two or three drops of [Pg 496] a twenty-five per cent solution of soda lye added thereto. Ether is poured in to the second mark, the tube closed and vigorously shaken. Alcohol of about ninety per cent strength is added to the upper mark, the tube closed, shaken and allowed to stand in a vertical position, with occasional jolting, until the separation of the liquids is complete. In order to promote the separation the tube is placed in a cylinder containing water at 40°.
When the separation is complete the milk serum is found at the bottom, the mixture of alcohol and ether in the middle and the fat at the top. The mixture of ether and alcohol contains 0.126 gram of fat, and each cubic centimeter of the separated ether fat 0.233 gram of fat. The total volume of the separated fat, multiplied by 0.233, and the product increased by 0.126, will give the weight of fat in the ten cubic centimeters of milk employed.
Example.—Milk used, ten cubic centimeters of 1.032 specific gravity = 10.32 grams. The observed volume of the saturated ether fat solution is two cubic centimeters. Then the weight of fat is 2 × 0.233 + 0.126 = 0.592 gram. The percentage of fat in the sample is 0.592 × 100 ÷ 10.32 = 5.74.
In the apparatus used in this laboratory the upper division of the graduation is marked 12.6, because this represents the quantity of fat which remains in the ether-alcohol mixture for one liter of milk. From this point the graduation is extended downward to ninety-five, which, for ten cubic centimeters of milk, represents 0.95 gram. After the fat has separated, enough ninety-five per cent alcohol is added to bring the upper surface exactly to the graduation 12.6. The number of grams per liter of milk is then read directly from the scale.
In respect of applicability, the observation made regarding Soxhlet’s areometric method may be repeated.
In practical work in this country the lactobutyrometer is no longer used, but many of the recorded determinations of fat in milk have been made by this method.
469. Volumetric Methods.—For practical purposes, the volumetric methods of estimating fat in milk have entirely superseded all the [Pg 497] other processes. It has been found that the fat readily separates in a pure state from the other constituents of milk whenever the casein is rendered completely soluble; whereas no process has yet been devised whereby the fat can be easily separated in a pure state from milk which has not been treated with some reagent capable of effecting a solution of the casein. The volumetric methods may be divided into two classes; viz., (1) Those in which the fat is separated by the simple action of gravity, and (2) those in which the natural action of gravity is supplanted by centrifugal motion. Each of these classes embraces a large number of variations and some of the typical ones will be described in the following paragraphs. As solvents for the casein a large number of reagents has been used, including alkalies and single and mixed acids. In practice, preference is given to the least complex and most easily prepared solvents.
470. Method Of Patrick.—A typical illustration of the method of collecting the fat after solution of the casein, without the aid of whirling, is found in the process devised by Patrick.[460]
The solvent employed is a mixture of acetic, sulfuric and hydrochloric acids, saturated with sodium sulfate, in the respective volumetric proportions of nine, five and two. The separation is accomplished in a large test tube drawn out near the top into a constricted neck which is graduated to measure the volume of the separated fat or to give direct percentage results.
The tube should have a content of about twenty-five cubic centimeters below the upper mark on the neck. In use 10.4 cubic centimeters of milk and a sufficient quantity of the mixed acids to fill it nearly to the upper mark are placed in the tube, together with a piece of pumice stone, and the mixture boiled. On cooling below 100°, the fat will separate and the volume thereof may be measured in the constricted portion of the tube. The volume of the fat may be converted into weight on multiplying by 0.88 at 60°, or more conveniently the percentage of fat be taken from a table. In practice, the tube is filled with the milk and acid mixture nearly up to the neck, its contents well mixed and additional acid mixture added until the liquid is raised in the tube above the neck. After mixing a second time, the contents are [Pg 498] boiled for five minutes and the fat allowed to collect in the expanded part of the tube above the neck. When the fat has collected, the mixture is boiled gently a second time for a few minutes. By this treatment the fat is mixed with the upper portions of the acid liquid and clarified. The clearing of the fat may be hastened by sprinkling over it a little effloresced sodium sulfate. The fat is brought into the graduated neck by opening a small orifice in the belly of the tube, which is closed by means of a rubber band. When the temperature has reached 60°, the space occupied by the fat is noted and the numbers obtained express the percentage of fat in the sample.
This process is illustrative of the principle of analysis, but is no longer used in analytical determinations.
471. The Lactocrite.—One of the earliest methods for fat estimation in milk, depending on the solution of the casein and the collection of the fat by means of whirling, is based on the use of a centrifugal machine known as the lactocrite. This apparatus is modeled very like the machine usually employed for creamery work,[461] and at one time was extensively used, but it has now given place to less troublesome and expensive machines. The acid mixture for freeing the fat of casein is composed of glacial acetic acid carrying five per cent of sulfuric. The samples of milk are heated with the acid mixture in test tubes provided with stoppers and short glass tubes to return the condensation products. The hot mixture is poured into a small metallic cylindrical cup holding about three cubic centimeters. This cup fits by means of an accurately ground shoulder on a metal casing, carrying inside a heavy glass graduated tube of small internal diameter. The excess of the milk mixture escapes through a small aperture in the metallic screw cap of the metal holder. The metal holder is cut away on both sides in order to expose the graduations on the glass tube. The glass tube is held water-tight by means of perforated elastic washers. Thus prepared the tubes are inserted in the radial holes of a revolving steel disk previously heated to a temperature of 60°. The whirling is accomplished in a few minutes by imparting to the steel disk a speed of about 6,000 revolutions per minute. At the end of this operation the fat is found in a clear column in the small glass tube and the number [Pg 499] of the divisions it occupies in this tube is noted. Each division of the scale represents one-tenth per cent of fat.
This apparatus is capable of giving accurate results when all its parts are in good working order. In this laboratory the chief difficulty which its use has presented is in keeping the joints in the glass metal tube tight.
This description of the apparatus is given to secure an illustration of the principle involved, a principle which has been worked out in later times into some of the most rapid and practical processes of estimating fat in milk.
472. Modification of Lindström.—Many modifications have been proposed for conducting the determination of fat by means of the lactocrite, but they do not involve any new principle and are of doubtful merit. In the modification suggested by Lindström, which has attained quite an extended practical application, the solvent mixture is composed of lactic and sulfuric acids and the butyrometer tubes are so changed as to permit the collection of the fat in the graduated neck after whirling, by means of adding water. The apparatus is also adjusted to secure the congelation of the fat column before its volume is noted.[462] The analyst can read the fat volume at his leisure when it is in the solid state and is not confused by changes of volume during the observation. The best acid mixture has been found to be composed of 100 volumes of lactic, an equal amount of acetic and fifteen volumes of sulfuric acids.[463]

Fig. 109.
Babcock’s Butyrometer
and Acid Measure.
473. The Babcock Method.—Among the many quick volumetric methods which have been proposed for the determination of fat in milk, none has secured so wide an application as that suggested by Babcock.[464]
The chief point of advantage in the use of this method is found in effecting the solution of the casein by means of sulfuric acid of about 1.83 specific gravity. By this reagent the casein is dissolved in a few moments without the aid of any other heat than that generated by mixing the milk with the reagent. The bottle in which the separation is made is shown in Fig. 109. The graduations on the neck are based on the use of eighteen grams of milk. To avoid the trouble of weighing, the milk [Pg 500] is measured from a pipette graduated to deliver eighteen grams of milk of the usual specific gravity. While it is true that normal milk may vary somewhat in its density, it has been found that a pipette marked at 17.6 cubic centimeters delivers a weight which can be safely assumed to vary but slightly from the one desired. The graduated bottle holds easily thirty-five cubic centimeters of liquid in its expanded portion and the volume of milk just noted is mixed with an equal volume of sulfuric acid, conveniently measured from the lip cylinder shown in the figure. The complete mixture of the milk and acid is effected by gently rotating the bottle until its contents are homogeneous. The final color of the mixture varies from dark brown to black.
While still hot, the bottles are placed in a centrifugal machine and whirled for at least five minutes. The most convenient machine, where it is available, is the one driven by a jet of steam. The revolutions of the centrifugal should be at least 700 per minute for a twenty inch and 1,200 for a twelve inch wheel. After five minutes the bottles are removed and filled to the upper mark or nearly so with hot water, replaced in the machine and whirled for at least one minute. The fat will then be found in a clearly defined column in the graduated neck of the bottle. In reading the scale, the extreme limits between the lowest point marked by the lower meniscus and the highest point marked by the edge of the upper meniscus are to be regarded as the termini of the fat column.
In testing cream by the babcock process, it may either be diluted until [Pg 501] the column of fat secured is contained in the graduated part of the neck or specially graduated bottles may be used.
Condensed Milk: In applying the babcock test to condensed milk, it is necessary to weigh the sample and to use only about eight grams.[465] This quantity is placed in the bottle and dissolved in ten cubic centimeters of water and the analysis completed as above. The reading noted is multiplied by eighteen and divided by the weight of the sample taken.
Skim Milk: In determining the fat in skim milk and whey, it is desirable to use a bottle of double the usual capacity, but with the same graduation on the neck. The percentage of fat noted is divided by two.
Cheese: Five grams are a convenient quantity of cheese to employ. To this quantity in the bottle are added fifteen cubic centimeters of hot water and the flask gently shaken and warmed until the cheese is softened. The treatment with acid and whirling are the same as described above. The noted reading is multiplied by eighteen and divided by five.
474. Solution in Amyl Alcohol and Hydrochloric and Sulfuric Acids.—Leffmann and Beam have proposed to aid the solution of the casein in sulfuric acid by the previous addition to the milk of a mixture of equal volumes of amyl alcohol and hydrochloric acid.[466] In this process the same graduated flasks may be used as in the babcock process, or a special flask may be employed. In this case the graduation of the neck is for fifteen cubic centimeters of milk, and each one and a half cubic centimeters is divided into eighty-six parts. The quantity of milk noted is placed in the flask, together with three cubic centimeters of the mixture of amyl alcohol and hydrochloric acid, and well shaken. To the mixture, sulfuric acid of 1.83 specific gravity is added until the belly of the flask is nearly full and the contents well mixed by shaking. When the casein is dissolved, the addition of the sulfuric acid is continued until the flask is filled to the upper mark and again the contents mixed. It is well to close the mouth of the flask with a stopper while shaking. The bottle is placed in a centrifugal and whirled for a few moments, when the fat is collected in the graduated neck and its volume noted. [Pg 502]
The process is also known in this country as the beimling method.[467] The fat separated in the above process is probably mixed with a little fusel oil, and therefore it is advisable to use the specially graduated bottle instead of one marked in absolute volumes.[468]
The method, when conducted according to the details found in the papers cited, gives accurate results, but is somewhat more complicated than the babcock process and is not now used to any great extent in analytical work.
475. Method of Gerber.—The method proposed by Gerber for estimating fat in milk is based on the processes of Babcock, Beimling and Beam already described. The tubes in which the decomposition of the milk and the measurement of the fat are accomplished are of two kinds, one open at only one end for milk and the other open at both ends for cheese. They are closed during the separation by rubber stoppers.[469]

Fig. 110. Gerber’s Butyrometers.
The apparatus have been greatly improved and simplified since the first description of them was published and have come into extensive use in Europe and to a limited extent in this country.[470]
[Pg 503] The butyrometer tubes are made of various sizes and shapes, but the most convenient are those noted above as shown in Fig. 110.
Before adding the strong sulfuric acid, one cubic centimeter of amyl alcohol is mixed with the milk in the butyrometer. This admixture serves to clarify the fat and render the reading more easy.
The centrifugal is run by hand, and the required speed of rotation is given it by means of a cord wrapped spirally about its axis, as shown in Fig. 111. The cord in the new machines is replaced by a leather strap working on a ratchet.

Fig. 111. Gerber’s Centrifugal.
The process is more speedy than that of Babcock, and the results have been shown by a large experience to be reliable and accurate.
The sulfuric acid employed is of 1.825 to 1.830 specific gravity. There is no danger of loss by the formation of volatile ethers where the quantity of amyl alcohol used does not exceed one cubic centimeter. In a comparison of the respective merits of the methods of Babcock, Thörner and Gerber, made by Hausamann, the first place is awarded to the Gerber process.[471] In the figure 110, the butyrometers marked 2, 5 [Pg 504] and 8 are for milk, and those numbered 1, 3 and 7 are for cream and cheese. In conducting the analysis, ten cubic centimeters of the sulfuric acid are placed in the butyrometer with one cubic centimeter of the amyl alcohol. When mixed, eleven cubic centimeters of the milk are added and the contents of the tube well mixed, the tube stoppered and placed in the centrifugal. The larger tubes, open at both ends, require double the quantities of the reagents mentioned. The measurements are made at about 15°.
Minute directions for conducting the analyses with milk, skim milk, buttermilk, cream, condensed milk, cheese and butter accompany each apparatus.
476. Kinds of Proteid Bodies in Milk.—The proteid bodies in milk are all found in at least partial solution. Some authorities state that a portion of the casein is present in the form of fine particles suspended after the manner of the fat globules.[472] The number and kind of proteid bodies are not known with definiteness. Among those which are known with certainty are casein, albumin, peptone and fibrin. The latter body was discovered in milk by Babcock.[473] Lactoglobulin and lactoprotein are also names given to imperfectly known proteid bodies in milk. Lactoprotein is not precipitated either by acids or by heat and is therefore probably a peptone. By far the greater part of the proteid matters in milk is casein. Casein has been called caseinogen by Halliburton,[474] and paracasein by Schulze and Röse.[475] Casein has intimate relations to the mineral matters in milk, and is probably itself made up of several proteid bodies of slightly differing properties. In general all that class of proteid matter contained in milk which is precipitated by rennet or a weak acid, or spontaneously on the development of lactic acid, is designated by the term casein, while the albumins and peptones in similar conditions remain in solution. Casein contains phosphorus, presumably as nuclein. Fibrin is recognized in milk by the reactions it gives with hydrogen peroxid or gum guiacum. The decomposition of hydrogen peroxid is not a certain test for fibrin, inasmuch as pus and many other bodies will produce the [Pg 505] same effect. If the milk decompose hydrogen peroxid, however, before and not after boiling, an additional proof of the presence of fibrin is obtained, since boiled fibrin does not act on the reagent.[476] The gum guiacum test is applied by dipping a strip of filter paper into the milk and drying. The solution of gum guiacum is applied to the dried paper and the presence of fibrin is recognized by the blue color which is produced. The fibrin is probably changed into some other proteid during the ripening of cream in which the fibrin is chiefly found. The albumin in milk is coagulated by boiling, while the casein remains practically unaffected when subjected to that temperature.
477. Estimation of Total Proteid Matter.—The total proteid matter in milk is determined by any of the general methods applicable to the estimation of total nitrogen, but the moist combustion method is by far the most convenient. From the total nitrogen, that which represents ammonia or other nonproteid nitrogenous bodies, is to be deducted and the remainder multiplied by an appropriate factor. Practically all the nitrogen obtained is derived from the proteid matters and, as a rule, no correction is necessary. The factors employed for calculating the weight of proteid matter from the nitrogen obtained vary from 6.25 to 7.04. It is desirable that additional investigations be made to determine the magnitude of this factor. It is suggested that provisionally the factor 6.40 be used. In the method adopted by the Association of Official Agricultural Chemists it is directed that about five grams of milk be placed in the oxidizing flask and treated without previous evaporation exactly as described for the estimation of total nitrogen in the absence of nitrates. The nitrogen obtained is multiplied by 6.25 to get the total proteid matter.[477] In order to prevent the too great dilution of the sulfuric acid, the milk may be evaporated to dryness or nearly so before oxidation. In this laboratory it is conveniently done by placing the milk first in the oxidizing flask, connecting this with the vacuum service and placing the flask in hot water. The aqueous contents of the milk are quickly given off at a temperature not exceeding 85°, and the time required is only a few minutes. [Pg 506]
The milk may also be dried in dishes made of thin glass or tin foil and, after desiccation, introduced with the fragments of the dishes into the oxidizing flask.
The preliminary drying in the oxidizing flask is recommended as the best.
Söldner oxidizes the nitrogen in human milk by boiling ten cubic centimeters thereof for three hours with twenty-five of sulfuric acid, fifty milligrams of copper oxid and three drops of a four per cent platinic chlorid solution, and, after distilling the ammonia, uses the factor 6.39 for calculating the proteid matter. According to this author human milk is much less rich in nitrogenous constituents than is generally supposed, containing not more than one and a half per cent thereof in average samples collected at least a month after parturition.[478]
478. Precipitation of Total Proteids with Copper Sulfate.—This method of throwing out the total proteids of milk is due to Ritthausen.[479] The proteids and fat are precipitated together by the addition of a measured volume of copper sulfate solution, containing 63.92 grams of the crystallized salt in one liter. The process, as modified by Pfeiffer, is conducted as follows:[480]
Ten grams of milk are diluted with ten times that much water, five cubic centimeters of the copper sulfate solution added and then soda lye solution drop by drop until the copper is just precipitated. This is determined by testing a few drops of the filtrate with soda lye, which, when the copper is precipitated, will give neither a turbidity nor a blue color.
The mixture is poured into a dry tared filter, the precipitate washed with hot water, dried to constant weight and weighed. The fat is removed from the dry pulverized mass by extraction with ether and the residue dried and weighed.
The quantity of copper oxyhydrate contained in the precipitate is calculated from the quantity of the copper solution used and amounts to 0.2026 gram. The casein thus prepared contains not only the copper compound named, but also some of the sodium sulfate formed on the addition of the soda lye and other mineral salts present in the milk and from which it is quite impossible to completely free it. There are also many other objections to the process, and the product is of such a nature as to render the data obtained by the method very doubtful. [Pg 507]
This method is chiefly valuable on account of its historical interest. Not only are the drying and weighing of the precipitate rendered unnecessary by the modern methods of determining nitrogen, but there are numerous sources of error which seem to throw doubt on the accuracy of the results. The copper hydroxid does not lose all its water even on drying at 125°.[481] The method therefore can only be recommended for practical purposes when all the tedious processes of drying, extracting and calculating the quantity of copper oxid are abandoned and the moist washed precipitate used directly for the determination of nitrogen.
479. Proteid Bodies by Ammonium Sulfate.—All the proteid bodies except peptones are precipitated from milk on saturation with ammonium sulfate. This method has little analytical value because of the presence of nitrogenous salt in the precipitate. Zinc sulfate may be substituted for the ammonium salt and thus a determination of proteid matter other than peptone be obtained. This result subtracted from the total proteid nitrogen gives that due to peptone.
480. Total Proteid Matter by Tannic Acid.—For the determination of the total proteid matter in milk Sebelien uses the following process.[482] From three to five grams are diluted with three or four volumes of water, a few drops of a saline solution added (sodium phosphate, sodium chlorid, magnesium sulfate, et similia), and the proteid bodies thrown out with an excess of tannic acid solution. The precipitate is washed with an excess of the precipitant and the nitrogen therein determined and multiplied by 6.37.
481. Separation of Casein from Albumin.—Sebelien prefers magnesium sulfate or sodium chlorid to acetic acid as the best reagent for separating casein from lactalbumin. Of the two saline reagents mentioned, the former is the better. The milk is first diluted with a double volume of the saturated saline solution and then the fine powdered salt added until saturation is secured. The casein is completely thrown out by this treatment, collected on a filter, washed with the saturated saline solution, and the nitrogen therein [Pg 508] determined. The difference between the total and casein nitrogen gives the quantity due to the albumin plus the almost negligible quantity due to globulin.[483]
482. Van Slyke’s Method of Estimating Casein.—The casein may be separated from the other albuminoids in milk by the procedure proposed by Van Slyke.[484] Ten grams of the fresh milk are diluted with ninety cubic centimeters of water and the temperature raised to 40°. The casein is thrown down with a ten per cent solution of acetic acid, of which about one and a half cubic centimeters are required. The mixture is well stirred and the precipitate allowed to subside. The whey is decanted onto a filter, and the precipitate washed two or three times with cold water, brought finally onto the filter and washed once or twice with cold water. The filter paper and its contents are used for the determination of nitrogen in the usual way. The casein is calculated from the nitrogen found by multiplication by the factor 6.25. Milk may be preserved for this method of determination by adding to it one part of finely powdered mercuric chlorid for each two thousand parts of the sample. The method is not applicable to curdled milk.
483. Theory of Precipitation.—Most authorities now agree in supposing that the state of semisolution in which the casein is held in milk is secured by the presence of mineral matters in the milk, in some intimate combination with the casein. Among these bodies lime is of the most importance. The action of the dilute acid is chiefly on these mineral bodies, releasing them from combination with the casein, which, being insoluble in the milk serum, is precipitated.
484. Factors for Calculation.—Most analysts still use the common proteid factor, 6.25, in calculating the quantity of proteids from the nitrogen determined by analysis. For casein many different factors have been proposed. According to Makeris the factor varies from 6.83 to 7.04.[485] Munk gives 6.34 for human and 6.37 for cow milk.[486] Sebelien adopts the latter factor, and Hammersten nearly the same; viz., 6.39. The weight of authority, at the present time, favors a factor considerably above 6.25 for calculating the casein and, in fact, the total proteids of milk from the weight of nitrogen obtained. [Pg 509]
485. Béchamp’s Method of Preparing Pure Casein.—The casein in about one liter of milk is precipitated by adding gradually about three grams of glacial acetic acid diluted with water. The addition of the acid is arrested at the moment when litmus paper shows a slightly acid reaction. The precipitate thus produced, containing all the casein, the milk globules and the microzymes, is separated by filtration, being washed by decantation before collecting it on the filter. On the filter it is washed with distilled water and the fat removed by shaking with ether. The residue is suspended in water, dissolved in the least possible quantity of ammonium carbonate, any insoluble residue (microzymes, globules) separated by filtration and the pure casein thrown out of the filtrate by the addition of acetic acid. The washing with distilled water, solution in ammonium carbonate, filtration and reprecipitation are repeated three or four times in order to obtain the casein entirely free of other substances. Casein thus prepared is burned to a carbon free ash with difficulty and contains but little over one-tenth per cent of mineral matter.[487]
486. Separation of Casein with Carbon Dioxid.—The supersaturation of the lime compounds of casein with carbon dioxid diminishes the solvent action of the lime and thus helps to throw out the proteid matter. For this reason Hoppe-Seyler recommends the use of carbon dioxid to promote the precipitation of the casein.[488] The milk is diluted with about twenty volumes of water and treated, drop by drop, with very dilute acetic acid as long as a precipitate is formed. A stream of pure carbon dioxid is conducted through the mixture for half an hour, and it is allowed to remain at rest for twelve hours, when the casein will have all gone down and the supernatant liquid will be clear. Albumins and peptones are not thrown out by this treatment.
The method of precipitation is advantageously modified by saturating the diluted milk with carbon dioxid before adding the acetic acid, less of the latter being required when used in the order just noted.[489]
487. Separation of Albumin.—In the filtrate from the casein [Pg 510] precipitate the albumin may be separated by heating to 80°. It may also be precipitated by tannic acid, in which case it may contain a little globulin. It may also be thrown out by saturation with ammonium or zinc sulfates. The latter reagent is to be preferred when the nitrogen is to be determined in the precipitate. The quantities of albumin and globulin, especially the latter, present in milk are small compared with its content of casein.
488. Separation of Globulin.—The presence of globulin in milk is demonstrated by Sebelien in the following manner:[490] The milk is saturated with finely powdered common salt and the precipitate produced is separated by filtration. This filtrate in turn is saturated with magnesium sulfate. The precipitate produced by this reagent is collected on a filter, dissolved in water and precipitated by saturation with sodium chlorid. This process is repeated several times. The final precipitate is proved to be globulin by the following reactions: When a solution of it is dialyzed the proteid body separates as a flocculent precipitate, which is easily dissolved in a weak solution of common salt. The clear solution thus obtained becomes turbid on adding water, and more so after the addition of a little acetic acid. A neutral solution of the body is also completely precipitated by saturation with sodium chlorid. These reactions serve to identify the body as a globulin and not an albumin. All the globulin in milk is not obtained by the process, since a part of it is separated with the casein in the first precipitation.
489. Other Precipitants of Milk Proteids.—Many other reagents besides those mentioned have been used for precipitating milk proteids, wholly or in part. Among these may be mentioned the dilute mineral acids, lactic acid, rennet, mercuric iodid in acetic acid, phosphotungstic acid, acid mercuric nitrate, lead acetate and many others.
It has been shown by the author that many of these precipitants do not remove all the nitrogen but that among others the mercury salts are effective.[491] When nitrogen is to be subsequently determined the acid mercuric nitrate cannot be employed. [Pg 511]
490. Precipitation by Dialysis.—Since the casein is supposed to be held in solution by the action of salts it is probable that it may be precipitated by removing these salts by dialysis.
491. Carbohydrates in Milk.—The methods of determining lactose in milk, both by the copper reduction and optical processes, have been fully set forth in foregoing paragraphs (243, 244, 259, 262). In general, the optical method by double dilution is to be preferred as practically exact and capable of application with the minimum consumption of time.[492] For normal milks a single polarization is entirely sufficient, making an arbitrary correction for the volume occupied by the precipitated proteids and fat. This correction is conveniently placed at six and a half per cent of the volume of milk employed.
The polarimetric estimation of lactose in human milk is likely to give erroneous results by reason of the existence in the serum of polarizing bodies not precipitable by the reagents commonly employed for the removal of proteids.[493] The same statement may be made in respect of ass and mare milk. The use of acetopicric acid for removing disturbing bodies, as proposed by Thibonet[494] does not insure results free from error. With the milks above mentioned, it is safer to rely on the data obtained by the alkaline copper reagents.
492. Dextrinoid Body in Milk.—In treating the precipitate, produced in milk by copper sulfate, with alcohol and ether for the purpose of removing the fat, Ritthausen isolated a dextrin like body quite different from lactose in its properties.[495] The alcohol ether extract evaporated to dryness leaves a mass not wholly soluble in ether, and therefore not composed of fat. This residue extracted with ether, presents flocky particles, soluble in water and mostly precipitated therefrom by alcohol. This body has a slight reducing effect on alkaline copper salts and produces a gray color with bismuth nitrate. The quantity of this material is so minute as to lead Ritthausen to observe that it does not sensibly affect the fat determinations when not separated. It is not clearly demonstrated that it is a dextrinoid body and the analyst need not fear that the optical determination of milk sugar will be sensibly affected thereby.
Raumer and Späth assume that certain discrepancies, observed by them in [Pg 512] the data obtained for lactose by the copper and optical methods, are due to the presence of this dextrinoid body, but no positive proof thereof is adduced.[496]
493. Amyloid Bodies in Milk.—Herz has observed in milk a body having some of the characteristics of starch.[497] Observed by the microscope, these particles have some of the characteristics of the starch grains of vegetables, with a diameter of from ten to thirty-five micromillimeters. They are colored blue by iodin. When boiled with water, however, these particles differ from starch in not forming a paste. The particles are most abundant in the turbid layer found immediately beneath the ether fat solution in the areometric process of Soxhlet.
The amyloid particles may be collected from cheese and butter by boiling with water, when they settle and can be observed on the sediment after freeing of fat by ether.
Some of the statements regarding the adulteration of dairy products with starch may have been made erroneously by reason of the natural occurrence of these particles.
As in the case of the dextrin like body mentioned above this starchy substance, if it really exist, occurs in too minute a quantity to influence the results of any of the analytical methods heretofore described.
In connection with the supposed presence of an amyloid body in milk, it should be remembered that certain decomposition nitrogenous bodies give practically the same reactions as are noted above.[498] Among these may be mentioned chitin, which occurs very extensively in the animal world. The proof of the existence of dextrinoid and amyloid bodies in milk rests on evidence which should be thoroughly revised before being undoubtedly accepted.
494. General Principles.—The general analysis of butter fat is conducted in accordance with the methods described in the part of this volume devoted to the examination of fats and oils. The methods of sampling, drying, filtering, and of determining physical and chemical properties, are there developed in sufficient detail to guide the [Pg 513] analyst in all operations of a general nature. There remain for consideration here only the special processes practiced in butter analysis and which are not applied to fats in general. These processes naturally relate to the study of those properties of a distinctive nature, by means of which butter is differentiated from other fats for which it may be mistaken or with which it may be adulterated. These special studies, therefore, are directed chiefly to the consideration of the peculiar physical properties of butter fat, to its content of volatile acids and to its characteristic forms of crystallization as observed with the aid of the microscope. For dietetic, economic and legal reasons, it is highly important that the analyst be able to distinguish a pure butter from any substitute therefor.
495. Appearance of Melted Butter.—Fresh, pure butter, when slowly melted, shows after a short time the butter fat completely separated, of a delicate yellow color and quite transparent. Old samples of butter do not give a fat layer of equal transparency. Oleomargarin, or any artificial butter when similarly treated, gives a fat layer opalescent or opaque. By means of this simple test an easy separation of pure from adulterated butter may be effected. In mixtures, the degree of turbidity shown by the separated fats may be regarded as a rough index of the amount of adulteration. In conducting the work, the samples of butter, in convenient quantities according to the size of the containing vessel, are placed in beakers and warmed slowly at a temperature not exceeding 50°. After a lapse of half an hour the observations are made.
If one part of the melted butter be shaken with two volumes of warm water (40°) and set aside for five minutes the fat is still found as an emulsion, while oleomargarin, similarly treated, shows the fat mostly separated. This process has some merit, but must not be too highly valued.[499]
496. Microscopic Examination of Butter.—The microscope is helpful in judging the purity of butter and the admixture of foreign fats, if not in too small quantity to be of any commercial importance, can easily be detected by this means.[500] The methods of preparing butter fat in a crystalline state are the same as those described in paragraphs 307-309. The crystals of butter [Pg 514] fat differ greatly in appearance with the different methods of preparation. When butter is melted, filtered, heated to the boiling point of water and slowly cooled, it forms spheroidal crystalline masses as seen by the microscope, which present a well defined cross with polarized light. This cross is not peculiar to butter fat, but is developed therein with greater distinctiveness than in other fats of animal origin.
Pure, fresh, unmelted butter, when viewed with polarized light through a plate of selenite, presents a field of vision of uniform tint, varying with the relative positions of the nicols. When foreign fats, previously melted, as in rendering, are mixed with the butter the crystallization they undergo disturbs this uniformity of tint and the field of vision appears particolored. Old, rancid or melted butter may give rise to the same or similar phenomena under like conditions of examination. The microscope thus becomes a most valuable instrument for sorting butters and in distinguishing them in a preliminary way from oleomargarin.

Fig. 112. Thermometer for Butyrorefractometer.
497. Judgment of Suspected Butter or Lard by Refractive Power.—In discriminating between pure and adulterated butters by the aid of the butyrorefractometer (301), the absolute reading of the instrument is of less importance than the difference which is detected between the highest permissible numbers, for any degree of temperature, and the actual reading obtained at that temperature. These differences, within certain limits, do not perceptibly vary with the temperature, and heretofore they have been determined with the aid of a table, and in this respect the observations have been made the more laborious.
Wollny has rendered these tables unnecessary by constructing a thermometer in which the mercury column does not indicate degrees of temperature, but the highest permissible number for butter or lard at the temperature of observation. The scale of the instrument is so adjusted as to include temperatures of from 30° to 40°, which renders it suited to the examination of butter and lard. The oleothermometer is shown in Fig. 112. [Pg 515]
The side of the scale B is for butter and that marked S for lard. The use of the instrument is the simplest possible. The sample of fat is placed in the prisms in the usual manner. When the mercury in the thermometer is at rest, the scale of the instrument is read. In the case of a butter, if the reading of the scale give a higher number than that indicated by the thermometer, the sample is pronounced suspicious and the degree of suspicion is proportional to the difference of the two readings.
498. Estimation of Water, Fat, Casein, Ash and Salt.—The methods proposed by the author for conducting these determinations, with minor amendments, have been adopted by the Association of Official Agricultural Chemists.[501]
Water.—The sample held in a flat bottom dish is dried to constant weight at about 100°. The weight of the sample used should be proportional to the area of the bottom of the dish, which should be just covered by the film of melted fat. The dish may be previously partly filled with sand, asbestos or pumice stone. The drying may take place in the air, in an inert gas or in a vacuum.
Fat.—The fat in a sample of butter is readily determined by treating the contents of the dish after the determination of water with an appropriate solvent.
The process is conducted as follows:
The dry butter from the water determination is dissolved in the dish with ether or petroleum spirit. The contents of the dish are then transferred to a weighed gooch with the aid of a wash bottle containing the solvent, and washed till free of fat. The crucible and contents are heated at the temperature of boiling water till the weight is constant. The weight of fat is calculated by difference from the data obtained.
The fat may also be determined by drying the butter on asbestos or sand, and subsequently extracting the fat by anhydrous alcohol free ether. The extract, after evaporation of the ether, is dried to constant weight at the temperature of boiling water and weighed. [Pg 516]
Casein or Curd and Ash.—The crucible containing the residue from the fat determination is covered and heated, gently at first, gradually raising the temperature to just below redness. The cover may then be removed and the heat continued till the contents of the crucible are white. The loss in weight of the crucible and contents represents casein or curd, and the residue is mineral matter or ash.
Salt.—It is the usual custom in the manufacture of butter in this country to add, as a condiment, a certain proportion of salt. In Europe, the butter offered for consumption is usually unsalted. A convenient method of determining the quantity of salt is found in the removal thereof, from the sample, by repeated washing with hot water and in determining the salt in the wash water by precipitation with silver nitrate. The operation is conducted as follows: From five to ten grams of the sample are placed in a separatory funnel, hot water added, the stopper inserted and the contents of the funnel well shaken. After standing until the fat has all collected on top of the water, the stopcock is opened and the water is allowed to run into an erlenmeyer, being careful to let none of the fat globules pass. Hot water is again added to the beaker, and the extraction is repeated several times, using each time from ten to twenty cubic centimeters of water. The resulting washings contain all but a mere trace of the sodium chlorid originally present in the butter. The sodium chlorid is determined in the filtrate by a set solution of silver nitrate, using a few drops of a solution of potassium chromate as an indicator.
It is evident that the quantity of salt may also be determined from the ash or mineral matter obtained, as above noted, by the same process. If desirable, which is rarely the case, the gravimetric method of estimating the silver chlorid may be used.
499. Volatile or Soluble Acids.—The distinguishing feature of butter, from a chemical point of view, is found in its content of volatile or soluble fat acids. Among the volatile acids are reckoned those which are carried over in a current of steam at a temperature only slightly higher than that of boiling water. As soluble acids are [Pg 517] regarded those which pass without great difficulty into solution in hot water. These two classes are composed essentially of the same acids. Of these butyric is the most important, followed by caproic, caprylic and capric acids. Small quantities or rather traces of acetic, lauric, myristic and arachidic acids are also sometimes found in butter. Palmitic, stearic and oleic acids also occur in large quantities. The above named acids, in combination with glycerol, form the butter fat.
500. Relative Proportion of Ingredients.—The composition of butter fat is given differently by different authorities.[502] A typical dry butter fat may be regarded as having the following composition:
| Per cent. | |
| Butyrin | 7.00 |
| Caproin, Caprylin and Caprin | 2.30 |
| Olein | 37.70 |
| Palmitin, stearin, etc. | 53.00 |
Pure butter fat consists principally of the above glycerids, some coloring principles, varying in quantity and composition with the food of the animal, and a trace of lecithin, cholesterol, phytosterol and a lipochrome.
501. Estimation of Volatile or Soluble Acids.—The volatile or soluble acids in butter fat are estimated by the methods already described (349, 351). In practice preference is given to the method of determining volatile acids, based on the principle that under standard conditions practically all the acids of this nature are secured in a certain volume of the distillate. This assumption is not strictly true, but the method offers a convenient and reliable manner of obtaining results which, if not absolute, are at least comparative.
The quantity of acid distilled is determined by titration with tenth normal alkali and for convenience the data are expressed in terms of the volume of the alkali consumed. Five grams of normal butter fat will give a distillate, under the conditions given, requiring about twenty-eight cubic centimeters of tenth normal alkali for complete saturation. This is known as the reichert-meissl number. Occasionally this number may rise to thirty-two or may sink to twenty-five. Cases [Pg 518] have been reported where it fell below the latter number, but such samples cannot be regarded as normal butter.
The determination of the reichert-meissl number is the most important of the chemical processes applied to butter fat analysis.
502. Saponification Value and Reichert Number.—It may often be convenient to make the same sample of butter fat serve both for the determination of the saponification value and of the reichert number. For this purpose it is convenient to use exactly five grams of the dry filtered fat. The saponification may be accomplished either under pressure or by attaching a reflux condenser to the flask as suggested by Bremer.[503] When the saponification, which is accomplished with alcoholic potash lye containing about 1.25 grams in each ten cubic centimeters of seventy per cent alcohol, is finished, and the contents of the flask are cooled, the residual alkali is titrated with a set sulfuric acid solution, using phenolphthalein as indicator. When the color has almost disappeared, an additional quantity of the indicator is added and the titration continued until the liquid is of an amber tint. A sample of the alkali, treated as above, is titrated at the same time and from the two sets of data obtained, the saponification number is calculated as indicated in paragraph (345).
A few drops of the alcoholic lye are added to the contents of the flask and the alcohol removed by evaporation. The residual soap and potassium sulfate are dissolved in 100 cubic centimeters of recently boiled water, some pieces of pumice added, and the volatile acids removed by distillation in the usual way after adding an excess of sulfuric acid. It is important to conduct blank distillations in the same form of apparatus to determine the magnitude of any corrections to be made. The size of the distilling flask and the form of apparatus to prevent mechanical projection of sulfuric acid into the distillate should be the same in all cases.
503. Modification of the Reichert-Meissl Method.—Kreis has proposed the use of strong sulfuric acid for saponifying the fats, the [Pg 519] saponification and distillation being accomplished in one operation. A source of error of some inconvenience in this method is due to the development of sulfurous acid by the reducing action of the organic matter on the oil of vitriol. Pinette proposes to avoid this difficulty by adding, before the distillation is begun, sufficient potassium permanganate to produce a permanent red coloration. By this means the sulfurous acid is completely oxidized and its transfer to the standard alkali during distillation entirely prevented. The same result is accomplished by Micko by the use of potassium bichromate. The details of the manipulation are as follows:[504]
About five grams of the fused fat (butter or oleomargarin) are placed in a flask of approximately 300 cubic centimeters capacity. After cooling, there are added ten cubic centimeters of sulfuric acid containing three grams of water to each ninety-seven grams of the strongest acid.
The fat and acid are well mixed by a gentle rotatory motion of the flask and placed in a water bath at a temperature of 35° (circa) for fifteen minutes. At the end of this time the flask is removed from the bath and 125 cubic centimeters of water added, little by little, keeping the contents cool. Next are added four cubic centimeters of a four per cent solution of potassium bichromate. The contents of the flask are vigorously shaken and, after five minutes, a solution of ferrous sulfate is added gradually from a burette until the reaction with a drop of potassium ferrocyanid shows a slight excess of the iron salt. The volume of the liquor in the flask is then increased to 150 cubic centimeters by the addition of water and 110 cubic centimeters distilled. After mixing and filtering through a dry filter, the acid in 100 cubic centimeters is determined by standard tenth normal barium hydroxid solution and the number thus obtained increased by one-tenth representing the total acid obtained.
504. Elimination of Sulfurous Acid.—Prager and Stern[505] propose to eliminate the sulfurous acid by a stream of air, succeeded by one of carbon dioxid, and proceed as follows: Five grams of the butter fat are brought into a liter flask, ten cubic centimeters of strong sulfuric acid are added and the flask is kept for ten minutes at [Pg 520] 30-32° with constant agitation. When the liquid is cold, air is bubbled through it until the odor of sulfurous acid has disappeared. One hundred cubic centimeters of water are added, with precautions against rise of temperature, and carbon dioxid is bubbled through for ten minutes. This is then displaced by a stream of air for another ten minutes, the delivery tube is washed into the flask with fifty cubic centimeters of water and the distillation is effected. The following results are quoted:
Cubic centimeters of tenth normal alkali required by five grams of butter fat:
| Reichert-Meissl. | Prager-Stern. | ||
| Sample | a | 29.86 | 29.60 |
| ” | b | 30.23 | 29.65 |
| ” | c | 28.34 | 27.76 |
| ” | d | 28.20 | 28.10 |
The authors do not comment on the possibility of loss of acids other than sulfurous in the stream of air, but they admit that further investigation is requisite to render the suggestion of Kreis serviceable.
505. Errors Due to Poor Glass.—The easy solubility of the glass holding the reagents is the cause of some of the difficulties attending the determination of the saponification value. The separated silica tends to carry down, mechanically, a part of the alkali. This is shown by the fact that after the color has been discharged by titration with acid and the flask set aside a reappearance of the red color is noticed, after a time, beginning at the bottom of the flask.[506] In order to avoid difficulties of this nature, either cold saponification should be practiced or the digestion vessels used for moist combustion in sulfuric acid be employed.
Errors may also be easily introduced by the use of uncalibrated burettes and from the employment of varying quantities of the phenolphthalein solution.
506. Estimation of the Molecular Weight of Butter and Butter Substitutes.—Garelli and Carono have proposed a method for discriminating between butter and its substitutes by the kryoskopic determination of molecular weights. [Pg 521]
The molecular weights of stearin, palmitin and olein are 890, 806 and 884, and of butyrin, caproin and caprylin 303, 386 and 470 respectively. Pure butter, therefore, has a lower mean molecular weight than margarin.
The method and apparatus of Beckmann are used in the determination, fifteen grams of benzol being employed as a solvent.
The constant for the molecular depression of the benzol is found to be 53.
The molecular weight obtained with samples of pure butter varied from 696 to 716, and for oleomargarin from 780 to 883.
The figures obtained with mixtures of twenty, twenty-five, thirty-three and fifty per cent of margarin with butter were 761, 720, 728 and 749 respectively. The method can be relied upon to classify samples as follows:
507. Substitutes and Adulterants of Butter.—In this country, butter is never adulterated with cocoa or sesame oil, as is sometimes the case in other lands. The common substitute for butter here is oleomargarin, and the most common butter adulterant, neutral lard. The methods of analyses, by means of which these bodies can be identified, have already been sufficiently described. By the use of certain digestive ferments and other bodies, butter may be made to hold an excessive quantity of casein, sugar and water in the form of a somewhat permanent emulsion.[508] This form of adulteration is revealed at once on melting the sample.
508. Furfurol Reaction with Sesame Oil.—Olive oil and sometimes butter are mixed with the cheaper body, sesame oil. The latter is detected with certainty, from the red coloration it gives when mixed with furfurol and hydrochloric acid. Instead of furfurol, some body yielding it when subjected to the action of hydrochloric acid, viz., sucrose or a pentose sugar, may be used. It has been found by Wauters, however, that an alcoholic solution of two grams of furfuraldehyd in 100 cubic centimeters of alcohol is the best reagent. One-tenth of a cubic centimeter of this reagent is used for each test.[509]
[Pg 522] The test is made as follows: The quantity of the furfuraldehyd solution mentioned above is mixed with ten cubic centimeters of hydrochloric acid, and there are added, without mixing, an equal volume of the suspected oil. On standing, a red coloration is produced at the zone of separation of the two liquids. If the oil be sesame, the coloration is produced instantly. As little as one per cent of sesame in a mixed oil will show the color in two minutes. The manipulation is also varied by shaking together the reagents and the melted butter. Turmeric, which is sometimes used in coloring butter, also gives the rose-red color when treated with hydrochloric acid, but turmeric supplies its own furfuraldehyd. It is easy to distinguish therefore the coloration due to sesame oil, which is developed only when furfuraldehyd is present, from that due to the turmeric, which is produced without the aid of the special reagent.
509. Butter Colors.—Where cows are deprived of green food and root crops, such as carrots, and kept on a poorly balanced ration, the butter made from their milk may be almost colorless. To remedy this defect it is quite a common practice to color the product artificially. Almost the sole coloring matter used in this country is anatto.[510] Other coloring matters which are occasionally employed are turmeric, saffron, marigold leaves, yellow wood (Chlorophora tinctoria), carrot juice, chrome yellow (lead chromate) and dinitrocresol.
The use of small quantities of anatto, turmeric or saffron is unobjectionable, from a sanitary point of view, but this is not the case with such a substance as lead chromate. The detection of anatto or saffron in butter may be accomplished by the method of Cornwall.[511] About five grams of the warm filtered fat are dissolved in about fifty cubic centimeters of ordinary ether, in a wide tube, and the solution is vigorously shaken for from ten to fifteen seconds, with from twelve to fifteen cubic centimeters of a very dilute solution of caustic potash or soda in water, only alkaline enough to give a distinct reaction with turmeric paper, and to remain alkaline after separating from the ethereal fat solution. The corked tube is set aside, and in a few hours, at most, the greater part of the aqueous solution, now [Pg 523] colored more or less yellow by the anatto, can be drawn from beneath the ether with a pipette or by a stopcock below, in a sufficiently clear state to be evaporated to dryness and tested in the usual way with a drop of concentrated sulfuric acid.
Sometimes it is well to further purify the aqueous solution by shaking it with some fresh ether before evaporating it, and any fat globules that may float on its surface during evaporation should be removed by touching them with a slip of filter paper; but the solution should not be filtered, because the filter paper may retain much of the coloring matter.
The dry yellow or slightly orange residue turns blue or violet blue with sulfuric acid, then quickly green, and finally brownish or somewhat violet this final change being variable, according to the purity of the extract.
Saffron can be extracted in the same way; it differs from anatto very decidedly, the most important difference being in the absence of the green coloration.
Genuine butter, free from foreign coloring matter, imparts at most a very pale yellow color to the alkaline solution; but it is important to note that a mere green coloration of the dry residue on addition of sulfuric acid is not a certain indication of anatto (as some books state) because the writer has thus obtained from genuine butter, free from foreign coloring matter, a dirty green coloration, but not preceded by any blue or violet-blue tint.
Blank tests should be made with the ether.
Turmeric is easily identified by the brownish to reddish stratum that forms between the ethereal fat solution and the alkaline solution before they are intimately mixed. It may be even better recognized by carefully bringing a feebly alkaline solution of ammonia in alcohol beneath the ethereal fat solution with a pipette, and gently agitating the two, so as to mix them partially.
Another method of separating artificial coloring matter has been proposed by Martin.[512]
A method of determining the relative amount of butter color has been [Pg 524] worked out by Babcock.[513]
510. Composition Of Cheese.—Pure cheese is made from whole milk by precipitating the casein with rennet. The precipitated casein carries down also the fat of the milk and a little lactose and whey remain incorporated with the cheesy mass. The ingredients of cheese are therefore those of the whole milk less the greater part of the whey, id est, milk sugar, lactalbumin, globulin, soluble mineral matters and water. In the conversion of the crude precipitate noted above into the cheese of commerce, it is subjected to a ripening process which is chiefly conditioned by bacterial action. It is not possible here to enter into a discussion of methods of isolating and identifying the bacteria which promote or retard the ripening process.[514] As a rule, about a month is required for the curing process, before the cheeses are ready for boxing and shipment. The most important changes during ripening take place in the proteid matter, which is so altered as to become more palatable and more digestible as a result of the bacterial activity.
The percentage composition of the principal cheeses of commerce are shown in the following table:[515]
| Water, Per cent. |
Casein, Per cent. |
Fat, Per cent. |
Sugar, Per cent. |
Ash, Per cent. |
|
|---|---|---|---|---|---|
| Cheddar | 34.38 | 26.38 | 32.71 | 2.95 | 3.58 |
| Cheshire | 32.59 | 32.51 | 26.06 | 4.53 | 4.31 |
| Stilton | 30.35 | 28.85 | 35.39 | 1.59 | 3.83 |
| Brie | 50.35 | 17.18 | 25.12 | 1.94 | 5.41 |
| Neufchatel | 44.47 | 14.60 | 33.70 | 4.24 | 2.99 |
| Roquefort | 31.20 | 27.63 | 33.16 | 2.00 | 6.01 |
| Edam | 36.28 | 24.06 | 30.26 | 4.60 | 4.90 |
| Swiss | 35.80 | 24.44 | 37.40 | 2.36 | |
| Full cream, | 38.60 | 25.35 | 30.25 | 2.03 | 4.07 |
| (mean of 143 analyses) |
It is evident that the composition of the cheese will vary with the milk from which it is made and the manipulation to which it is subjected. A good American green cheese made from milk of the composition noted below will have the composition which is appended.[516]
Table Showing Mean Composition of
Milk and Cheese Made Therefrom.
| Milk. | Cheese. | |||
|---|---|---|---|---|
| Per | cent. | water | 87.38 | 36.70 |
| ” | ” | fat | 3.73 | 34.18 |
| ” | ” | proteids | 3.13 | 23.44 |
| ” | ” | sugar, ash etc. | 5.76 | 5.68 |
[Pg 525] From the above it is seen that in full milk cheese the ratio of fat to casein is 1.46: 1, and to solids not fat 1.17: 1. This is a point of some importance in judging the purity of a cheese. When the full milk of a mixed herd is used the percentage of fat in a cheese will always be considerably higher than that of casein.
511. Manipulation of the Milk.—When sweet milk is received at the cheese factory, a starter of sour milk is added to it in order to hasten its ripening. When it is thought that the proper degree of acidity has been secured, it is subjected to a rennet test. In this test 160 cubic centimeters of the milk are heated to 30° and mixed with five cubic centimeters of the rennet solution made by diluting five cubic centimeters of the rennet of commerce with fifty cubic centimeters of water. The number of seconds required for the milk to curdle is noted. The observation is facilitated by distributing throughout the milk a few fine fragments of charcoal. The contents of the vessel are given a circular motion and, at the moment of setting, the movement of the black particles is suddenly arrested. If coloring matter be added to the milk, it should be done before it becomes sour. The quantity of rennet required is determined by the nature of the cheese which it is desired to make. For a cheese to be rapidly cured, enough rennet should be added to produce coagulation in from fifteen to twenty minutes, and when slow curing is practiced in from thirty to forty-five minutes. When the mass is solid so that it can be cut with a knife, the temperature is raised to 37°, and it is tested on a hot iron until it forms threads an eighth of an inch in length. This test is made by applying an iron heated nearly to redness to the curd. When the curd is in proper condition threads from a few millimeters to two centimeters in length are formed, when the iron is withdrawn. The longer threads indicate, but only to a limited extent, a higher degree of acidity.[517] This test is usually made about two and one-half hours from the time of coagulation. The whey is then drawn off through a strainer and the curd is placed on racks with linen bottoms in order that the residual whey may escape, the curd being stirred meanwhile. In from fifteen to twenty [Pg 526] minutes it can be cut into blocks eight or ten inches square and turned over. This is repeated several times in order to facilitate the escape of the whey. When the curd assumes a stringy condition, it is run through a mill and cut into small bits and is ready for salting, being cooled to 27° before the salt is added. From two to three pounds of salt are used for each 100 pounds of curd. The curd is then placed in the molds and pressed into the desired form. The cheeses thus prepared are placed on shelves in the ripening room and the rinds greased. They should be turned and rubbed every day during the ripening, which takes place at a temperature of from 15° to 18°.[518]
512. Official Methods of Analysis.—The methods of cheese analysis recommended by the Association of Official Agricultural Chemists are provisional and are not binding on its members. They are as follows:[519]
Preparation of Sample.—Where the cheese can be cut, a narrow wedge reaching from the edge to the center will more nearly represent the average composition than any other sample. This should be chopped quite fine, with care to avoid evaporation of water, and the several portions for analysis taken from the mixed mass. When the sample is obtained with a cheese trier, a plug perpendicular to the surface one-third of the distance from the edge to the center of the cheese more nearly represents the average composition than any other. The plug should either reach entirely or half way through the cheese. For inspection purposes the rind may be rejected, but for investigations where the absolute quantity of fat in the cheese is required the rind should be included in the sample. It is well, when admissible, to secure two or three plugs on different sides of the cheese, and, after splitting them lengthwise with a sharp knife, use portions of each for the different determinations.
Determination of Water.—From five to ten grams of cheese are placed in thin slices in a weighed platinum or porcelain dish which contains a small quantity of freshly ignited asbestos to absorb the fat. The dish is heated in a water oven for ten hours and weighed; the loss in weight is considered as water. If preferred, the dish may be placed in a desiccator over concentrated sulfuric acid and dried to [Pg 527] constant weight. In some cases this may require as much as two months. The acid should be renewed when the cheese has become nearly dry.
Determination of Ether Extract.—Grind from five to ten grams of cheese in a small mortar with about twice its weight of anhydrous copper sulfate. The grinding should continue until the cheese is finely pulverized and evenly distributed throughout the mass, which will have a uniform light blue color. This mixture is transferred to a glass tube having a strong filter paper, supported by a piece of muslin, tied over one end. Put a little anhydrous copper sulfate into the tube next to the filter before introducing the mixture containing the cheese. On top of the mixture place a tuft of ignited asbestos, and place the tube in a continuous extraction apparatus and treat with anhydrous ether for fifteen hours. Dry the fat obtained at 100° to constant weight.
Determination of Nitrogen.—The nitrogen is determined by the kjeldahl method, using about two grams of cheese, and multiplying the percentage of nitrogen found by 6.25 for proteid compounds.
Determination of Ash.—The dry residue from the water determination may be used for the ash determination. If the cheese be rich in fat, the asbestos will be saturated therewith. This may be carefully ignited and the fat allowed to burn, the asbestos acting as a wick. No extra heat should be applied during this operation, as there is danger of spurting. When the flame has died out, the burning may be completed in a muffle at low redness. When desired, the salt may be determined in the ash in the manner specified under butter (498).
Determination of Other Constituents.—The sum of the percentages of the different constituents, determined as above, subtracted from 100 will give the amount of organic acids, milk sugar etc., in the cheese.
513. Process of Mueller.—The process of Müller,[520] as modified by Kruger,[521] is conducted as follows: About ten grams of a good average sample of cheese are rubbed in a porcelain mortar with a mixture of three parts of alcohol and one part of ether. After the mixed liquids have been in [Pg 528] contact with the cheese five or ten minutes they are poured upon a weighed filter of from fifteen to sixteen centimeters diameter, and this process is repeated from one to three times, after which the contents of the mortar are brought upon the filter. The filtrate is received in a weighed flask, the alcohol ether driven off by evaporation and the residue dried. Since it is difficult to get all the particles of cheese free from the mortar, it is advisable to perform the above process in a weighed dish which can afterwards be washed thoroughly with ether and alcohol and dried and the amount of matter remaining thereon accounted for. The residue remaining in the flask after drying is treated several times with pure warm ether, and the residue also remaining upon the filter mentioned above is completely extracted with ether. The dried residue obtained in this way from the filter plus the residue in the flask which received the filtrate, plus the amount left upon the dish in which the cheese was originally rubbed up, constitute the total dry matter of the cheese freed of fat. All the material soluble in ether should be collected together, dried and weighed as fat.
By this process the cheesy mass is converted into a fine powder which can be easily and completely freed from fat by ether, and can be dried without becoming a gummy or horny mass.
For the estimation of the nitrogen, about three grams of the well grated cheese are used and the nitrogen determined by moist combustion with sulfuric acid.[522]
For the estimation of ash, about five grams are carbonized, extracted with water, and the ash determined as described below.[523]
Char from two to three grams of the substance and burn to whiteness at the lowest possible red heat. If a white ash cannot be obtained in this manner, exhaust the charred mass with water, collect the insoluble residue on a filter, burn, add this ash to the residue from the evaporation of the aqueous extract and heat the whole to a low redness till the ash is white.
514. Separation of Fat from Cheese.—It is often desirable to secure a considerable quantity of the cheese fat for physical and chemical examination without the necessity of effecting a complete quantitive separation. In this laboratory this is accomplished by the method of Henzold.[524] The cheese, in quantities of about 300 grams, is cut into fragments [Pg 529] about the size of a pea and treated with 700 cubic centimeters of potash lye, which has previously been brought to a temperature of about 20°. The strength of the lye should be such that about fifty grams of the caustic potash are contained in each liter of the solution.
The treatment is conveniently conducted in a wide neck flask and the solution of the casein is promoted by vigorous shaking. After from five to ten minutes, it will be found that the casein is dissolved and the fat is found swimming upon the surface of the solution in the form of lumps. The lumps of fat are collected in as large a mass as possible by a gentle shaking to and fro. Cold water is poured into the flask until the fat is driven up into the neck, whence it is removed by means of a spoon.
The fat obtained in this way is washed a few times with as little cold water as possible in order to remove the residue of potash lye which it may contain. Experience shows that the fat by this treatment is not perceptibly attacked by the potash lye. In a short time, by this procedure, the fat is practically all separated and is then easily prepared for chemical analysis by filtering and drying in the manner already described (283). The fat may also be separated, but with less convenience, by partially drying the sample, reducing it to a finely divided state and applying any of the usual solvents. The solvent is removed from the extract by evaporation and the residual fat is filtered and prepared for examination as usual.
515. Filled Cheese.—The skim milk coming from the separators is unfortunately too often used for cheese making. The abstracted fat is replaced with a cheaper one, usually lard. These spurious cheeses are found in nearly every market and are generally sold as genuine. The purchasers only discover the fraud when the cheese is consumed. Many of the States have forbidden by statute the manufacture and sale of this fraudulent article. Imported cheeses may also be regarded with suspicion, inasmuch as the method of preparing filled cheese is well known and extensively practiced abroad. A mere determination of the percentage of fat in the sample is not an index of the purity of the cheese. It is necessary to extract the fat by one of the methods already described and, after drying and filtering, to submit the suspected fat to a microscopic and chemical examination. A low content [Pg 530] of volatile fat acid and the occurrence of crystalline forms foreign to butter will furnish the data for a competent judgment.
When the reichert-meissl number falls below twenty-five the sample may be regarded with suspicion. The detection of the characteristic crystals of lard or tallow is reliable corroborating evidence (308).
It is stated by Kühn[525] that the margarin factory of Mohr, at Bahrenfeld-Altona, has made for many years a perfect emulsion of fat with skim milk. This product has been much used in the manufacture of filled cheese which is often found upon the German market.
516. Separation of the Nitrogenous Bodies in Cheese.—The general methods of separation already described for proteid bodies (417-425) are also applicable to the different nitrogenous bodies present in cheese, representing the residue of these bodies as originally occurring in the milk, and also the products which are formed therefrom during the period of ripening. For practical dietary and analytical purposes, these bodies may be considered in three groups:
(a) The useless (from a nutrient point of view) nitrogenous bodies, including ammonia, nitric acid, the phenylamido-propionic acids, tyrosin, leucin and other amid bodies.
(b) The albumoses and peptones, products of fermentation soluble in boiling water.
(c) The caseins and albuminates, insoluble in boiling water.
The group of bodies under (a), according to Stutzer, may be separated from the groups (b) and (c) by means of phosphotungstic acid. For this purpose a portion of an intimate mixture of fine sand and cheese (100 cheese, 400 sand) corresponding to five grams of cheese, is shaken for fifteen minutes with 150 cubic centimeters of water. After remaining at rest for another fifteen minutes 100 cubic centimeters of dilute sulfuric acid (one acid, three water) are added, followed by treatment with the phosphotungstic acid as long as any precipitate is produced. The mixture is thrown on a filter and the insoluble matters washed with dilute sulfuric acid until the filtrate amounts to half a liter. Of this quantity an aliquot part (200 cubic centimeters) is used for the determination of nitrogen. From [Pg 531] the quantity of nitrogen found, that representing the ammonia, as determined in a separate portion, is deducted and the remainder represents the nitrogen present in the cheese as amids.[526]
Albumoses and Peptones.—Albumoses and peptones are determined in cheese by the following method:[527] A quantity of the sand mixture already described, corresponding to five grams of the cheese, is treated with about 100 cubic centimeters of water, heated to boiling, and the clear liquid above the sand poured into a flask of half a liter capacity. The extraction is continued with successive portions of water in like manner until the volume of the extract is nearly half a liter. When cold, the volume of the extract is completed to half a liter with water, the liquor filtered, 200 cubic centimeters of the filtrate treated with an equal volume of dilute sulfuric acid (one to three) and phosphotungstic acid added until no further precipitate takes place. The nitrogen is determined in the precipitate after filtration and washing with dilute sulfuric acid.
Casein and Albuminates.—The quantity of casein and albuminates in cheese is calculated by subtracting from the total nitrogen that corresponding to ammonia, amids, that in the indigestible residue and that corresponding to the albumose and peptone. In three samples of cheese, viz., camembert, swiss, and gervais, Stutzer found the nitrogen, determined as above, distributed as follows:[528]
| Camembert. | Swiss. | Gervais. | |
| N as ammonia | 13.0 | 3.7 | 1.6 |
| N as amids | 38.5 | 9.0 | 5.2 |
| N as albumose peptone | 30.5 | 8.6 | 15.5 |
| N indigestible | 4.0 | 2.4 | 8.6 |
| N as casein, albuminates | 14.0 | 76.3 | 69.1 |
Ammoniacal Nitrogen.—The ammoniacal nitrogen is determined by mixing a quantity of the sand-cheese corresponding to five grams of cheese, with 200 cubic centimeters of water, adding an excess of barium carbonate and collecting the ammonia by distillation in the usual way.
Digestible Proteids.—The digestible proteids in cheese are determined by the process of artificial digestion, which will be described in the part of this volume treating of the nutritive value of foods. [Pg 532]
These data show the remarkable changes which the proteids undergo where the ripening is carried very far as in the camembert cheese.
517. Koumiss.—Fermented mare milk has long been a favorite beverage in the East, where it is known as koumiss. In Europe and this country cow milk is employed in the manufacture of fermented milk, although it is less rich in lactose than mare milk. The process of manufacture is simple, provided a suitable starter is at hand. A portion of a previous brewing is the most convenient one, the fermentation being promoted by the addition of a little yeast. After the process of fermentation is finished the koumiss is placed in bottles and preserved in a horizontal position in a cellar, where the temperature is not allowed to rise above 12°.
518. Determination of Carbon Dioxid.—The carbon dioxid in koumiss is conveniently estimated by connecting the bottle by means of a champagne tap with a system of absorption bulbs.[529] The exit tube from the koumiss bottle passes first into an erlenmeyer, which serves to break and retain any bubbles that pass over. The water is next removed by means of sulfuric acid. The koumiss bottle is placed in a bath of water which is raised to the boiling point as the evolution of the gas is accomplished. The arrangement of the apparatus is shown in Fig. 113. At the end of the operation any residual carbon dioxid in the apparatus is removed by aspiration after removing the tap and connecting it with a soda-lime tube to hold the carbon dioxid in the air. A large balance suited to weighing the koumiss bottle is required for this determination. The carbon dioxid may also be determined, but less accurately, by loss of weight in the koumiss bottle after adding weight of water retained in the apparatus.
519. Acidity.—Although koumiss may contain a trace of acetic acid, it is best to determine the acid as lactic. The clarification is most easily accomplished by mixing the koumiss with an equal volume of ninety-five per cent alcohol, shaking and filtering. The first filtrate will usually be found clear. If not it is refiltered. In an aliquot part of the filtrate the acidity is determined by titration with tenth-normal sodium hydroxid solution, using phenolphthalein as indicator. The necessary corrections for dilution and volume of the precipitated casein are to be made. A linen filter may be used when paper is found too slow. [Pg 533]

Fig. 113. Apparatus for Determining Carbon Dioxid in Koumiss.
[Pg 534] 520. Alcohol.—Half a liter of koumiss, to which 100 cubic centimeters of water have been added, is distilled until the distillate amounts to 500 cubic centimeters.
If the distillate be turbid 100 cubic centimeters of water are added and the distillation repeated. The alcohol is determined by the processes described hereafter.
521. Lactose.—The milk sugar may be determined by any of the methods described, but most conveniently by double dilution and polarization (86).
522. Fat.—Evaporate twenty grams of the sample to dryness and extract with pure ether or petroleum spirit in the manner already described (455).
The analysis is more quickly accomplished by the volumetric method of Babcock or Gerber (473-475).
523. Proteids.—The total proteids are most easily estimated by the official kjeldahl method.[530] The separation of the proteid bodies is accomplished by the methods described in paragraphs 475-489.
In addition to the methods already described for separating the soluble and suspended proteid bodies in milk, and which may be used also for koumiss, the following should also be mentioned as of especial worth:
Separation by Filtration through Porous Porcelain.—A purely physical method, and one which is to be recommended by reason of the absence of any chemical action upon the different proteid matters, is that proposed by Lehmann, depending upon the principle that when milk is forced through porous porcelain, the albumin passes through together with the milk, sugar and other soluble constituents as a clear filtrate, while the casein and fat are perfectly retained.[531]
By this method it is quite certain that the albumin and other perfectly soluble proteids of milk may be obtained in the purest form. [Pg 535]
Separation by Precipitation with Alum.—Probably the best chemical method of separating the two classes of proteid matters is that proposed by Schlosmann, which is effected by means of precipitating the casein with a solution of alum.[532]
The principle of this separation rests upon the fact that a solution of potash alum, when added to milk diluted with four or five times its volume of water, will completely separate the casein without affecting the albumin or globulin. The operation is conducted as follows:
Ten cubic centimeters of the milk are diluted with from three to five times that quantity of water and warmed to a temperature of about 40°. One cubic centimeter of a concentrated solution of potash alum is added, the mixture well stirred and the coagula which are formed allowed to subside. If the coagulation of the casein does not take place promptly, a small addition of the alum solution is made, usually not exceeding half a cubic centimeter, until the precipitation is complete. The temperature during the process should be kept as nearly as possible 40°. After a few minutes, the mixture is poured upon a filter and the filtrate, if not perfectly clear, is poured back until it is secured free of turbidity. In difficult cases the filtration may be promoted by the addition of some common salt or calcium phosphate, the latter acting mechanically in holding back the fine particles of casein. The precipitate is washed with water at a temperature of 40°, and afterwards with alcohol, not allowing the alcohol wash water to flow into the filtrate. When the water has been chiefly removed from the precipitate by washing with alcohol, the fat of the precipitated casein is removed with ether and the residue used for the determination of nitrogen in the usual way. The albumin is removed from the filtrate by a tannin solution in the manner already described (480). If it be desired to separate the albumin and globulin, the methods described in paragraph 399 may be used.
524. Mercurial Method.—A volumetric method for determining the total proteid matter in milk has lately been proposed by Deniges.[533] It is based upon the observation that in the precipitation of proteid [Pg 536] matter by mercury salts, a definite quantity of mercury in proportion to the amount of proteid, is carried down therewith. The precipitation is made with a mercurial salt of known strength and the excess of the mercurial salt in the filtrate is determined by titration. For the details of the manipulation, the paper cited above may be consulted.
525. Water and Ash.—From two to five grams of the koumiss are dried to constant weight in a flat platinum dish over ignited sand, asbestos or pumice stone, and the dried residue incinerated.
526. Composition of Koumiss.—The composition of koumiss varies with the character of the milk used and the extent of the fermentation. Some of the data obtained by analysts are given below:[534]
Composition of Koumiss.
| Kind of milk. | Water, Per cent. |
Sugar, Per cent. |
Alcohol, Per cent. |
Fat, Per cent. |
Proteid, Per cent. |
Carbon dioxid, Per cent. |
Acidity, Per cent. |
|---|---|---|---|---|---|---|---|
| Cow | 89.32 | 4.38 | 0.76 | 2.08 | 2.56 | 0.83 | 0.47 |
| Probably cow skim’d | 3.95 | 1.38 | 0.88 | 2.89 | 0.82 | ||
| Mare | 91.87 | 0.79 | 2.89 | 1.19 | 1.91 | 1.04 |
From the above it is seen that koumiss is made either from whole or skim milk, and that the percentage of alcohol may vary within large limits, its proportion being inverse to that of the milk sugar.
Koumiss is a beverage which is very palatable, easily digested and one which is not appreciated in this country in proportion to its merits, especially for the use of invalids.
[400] Wiley; Proceedings of the Society for the Promotion of Agricultural Science, 1889, p. 84. (Omit “food” before idiosyncrasy.)
[401] Pharmaceutical Journal and Transactions, Series 3, Vol. 18, p. 479.
[402] The Analyst, 1892, p. 85.
[403] Henkel; Wiener Landwirtschaftliche Zeitung, 1888, S. 401: Bulletin No. 24, Division of Chemistry, U. S. Department of Agriculture, p. 155.
[404] Die Landwirtschaftlichen Versuchs-Stationen, Band 35, S. 351: Bulletin No. 24, Division of Chemistry, U. S. Department of Agriculture, p. 151.
[405] Baumeister; Milch und Molkerei-Producte, S. 16.
[406] Bulletins Nos. 9 and 25 of the Office of Experiment Stations, U. S. Department of Agriculture: Farmers’ Bulletins Nos. 9 and 29, U. S. Department of Agriculture.
[407] Annales de Chimie et de Physique, 3e Série, Tome 64, p. 61.
[408] Bulletin de la Société Chimique de Paris, 3ᵉ Série, Tome 15-16, p. 248.
[409] Vid. op. cit. supra, p. 453.
[410] Central-Blatt für medicinische Wissenschaft, Band 34, S. 145.
[411] Conn; Farmers’ Bulletins 9 and 25, Office of Experiment Stations, U. S. Department of Agriculture: Farmers’ Bulletins 9 and 29, Department of Agriculture: Les Microbes et leur Rôle dans la Laiterie Freudenreich: Langlois, Le Lait, pp. 95 et seq.
[412] The Analyst, Vol. 20, p. 157.
[413] Vid. op. cit. supra, p. 152.
[414] Forschungs-Berichte über Lebensmittel etc., Band 2, S. 368.
[415] Vid. op. cit. supra, Band 1, S. 422.
[416] Vid. op. cit. supra, S. 372.
[417] Hopkins and Powers; Bulletin No. 47, Division of Chemistry, U. S. Department of Agriculture, p. 127.
[418] Bulletin No. 38, Division of Chemistry, U. S. Department of Agriculture, p. 118.
[419] Becke; Die Milchprüfungs-Methoden, S. 45: Rouvier; Le Lait, p. 45.
[420] The Analyst, 1890, Vol. 16, p. 170.
[421] Rouvier; Le Lait, p. 35.
[422] Central-Blatt für Nahrungs und Genussmittel Chemie, Band 13, S. 277.
[423] Bulletin No. 46, Division of Chemistry, U. S. Department of Agriculture, p. 36.
[424] Journal für Landwirtschaft, 1882, S. 293; 1885, S. 251.
[425] Vid. op. cit. supra, 1879, S. 249.
[426] Forschungen auf dem Gebiete der Viehhaltung, 1879, S. 265.
[427] The Analyst, Vol. 7, p. 129.
[428] Vid. op. cit. supra, Vol. 13, p. 26.
[429] Bulletin No. 47, Division of Chemistry, U. S. Department of Agriculture, p. 123.
[430] This work, Vol. 1, page 411.
[431] Bulletin No. 16, Division of Chemistry, U. S. Department of Agriculture, p. 36.
[432] Sixth Annual Report Wisconsin Agricultural Experiment Station, p. 64.
[433] Fourth Annual Report New York (Geneva) Agricultural Experiment Station, p. 298.
[434] Woll; Seventh Annual Report Wisconsin Agricultural Experiment Station, p. 238.
[435] The Analyst, 1885, p. 46: Bulletin No. 13, Part 1, Division of Chemistry, U. S. Department of Agriculture, p. 86.
[436] Haidlen; Die Milchprüfungs-Methoden, S. 12.
[437] Dingler’s polytechnisches Journal, Band 232, S. 461.
[438] Macfarlane; The Analyst, Vol. 18, p. 73.
[439] Duclaux; Le Lait, p. 176.
[440] Abraham; The Analyst, Vol. 9, p. 22.
[441] Gantter; Zeitschrift für analytische Chemie, Band 26, S. 677.
[442] Morse, Piggot and Burton; American Chemical Journal, Vol. 9, pp. 108 and 222.
[443] Chemiker-Zeitung Repertorium, 1889, S. 228.
[444] Journal de Pharmacie et de Chimie, 1890, p. 460.
[445] Richmond; The Analyst, Vol. 17, p. 48: Bulletins 28, 31, 35, 38, 43, and 46, Division of Chemistry, U. S. Department of Agriculture.
[446] Bulletin No. 28, Division of Chemistry, U. S. Department of Agriculture, p. 31.
[447] Zeitschrift für analytische Chemie, Band 27, S. 464.
[448] Chemical News, Nov. 1889.
[449] The Analyst, Vol. 16, p. 67.
[450] Vid. op. cit. supra, Vol. 18, p. 53.
[451] Vid. op. cit. supra, Vol. 17, p. 81.
[452] Chemiker-Zeitung, Band 15, S. 1833.
[453] Journal of Analytical Chemistry, 1888, Vol. 2, p. 371: Fifth Annual Report Wisconsin Agricultural Experiment Station.
[454] Molkerei Zeitung, 1892, No. 1; Chemisches Central-Blatt, 1892, Band 2, S. 429.
[455] Chemiker-Zeitung, Band 18, S. 1816; Band 19, S. 348.
[456] Zeitschrift für analytische Chemie, Band 32, S. 168.
[457] Zeitschrift des Landwirtschaftlichen Vereins in Bayern, 1880; Zeitschrift für analytische Chemie, Band 20, S. 452.
[458] Bulletin No. 13, Division of Chemistry, U. S. Department of Agriculture, p. 92.
[459] Instruction sur l’Emploi du Lactobutyrometer, Paris, 1856 et 1878: Becke; Die Milchprüfungs-Methoden, S. 66.
[460] Bulletin No. 8, Iowa Agricultural Experiment Station, p. 295.
[461] Dingler’s polytechnisches Journal, Band 261, S. 219.
[462] Milch Zeitung, Band 21, S. 496.
[463] Op. cit. supra, Band 22, S. 85.
[464] Bulletin No. 24, Wisconsin Agricultural Experiment Station.
[465] Bulletin No. 31, Wisconsin Agricultural Experiment Station.
[466] The Analyst, Vol. 17, p. 83.
[467] Bulletin No. 21, Vermont Agricultural Experiment Station.
[468] Vid. op. cit. 67, Vol. 17, p. 144; Vol. 18, p. 130; Vol. 19, p. 62.
[469] Chemiker-Zeitung, Band 16, S. 1839.
[470] Vid. op. cit. supra, Band 19, S. 348; Band 18, S. 1816.
[471] Vid. op. cit. supra, Band 19, S. 348.
[472] Comptes rendus, Tome 107, p. 772; Hoppe-Seyler’s Handbuch der Physiologisch- und Pathologisch-Chemischen Analyse, S. 479.
[473] Proceedings of the Society for the Promotion of Agricultural Science, 1888, p. 13.
[474] Journal of Physiology, Vol. 11, p. 459.
[475] Die Land wirtschaftlichen Versuchs-Stationen, Band 31, S. 131.
[476] Sixth Annual Report of the Wisconsin Agricultural Experiment Station, p. 64.
[477] Bulletin No. 46, Division of Chemistry, U. S. Department of Agriculture, p. 36.
[478] Zeitschrift für Biologie, Band 33, S. 43.
[479] Journal für praktische Chemie, {2}, Band 15, S. 329.
[480] Vid. op. cit. 79, Band 33, {Neue Folge, 15}, S. 55.
[481] Stenberg; Zeitschrift für physiologische Chemie, Band 13, S. 138.
[482] Vid. op. cit. supra, S. 137.
[483] Vid. op. cit. supra, S. 160.
[484] Journal of the American Chemical Society, Vol. 15, p. 644.
[485] Handbuch der Physiologisch- und Pathologisch-Chemischen Analyse, S. 285. (Read, Makris instead of Makeris.)
[486] Zeitschrift für Biologie, Band 23, S. 64.
[487] Bulletin de la Société Chimique de Paris, 3ᵉ Série, Tome 11, p. 152.
[488] Vid. op. cit. 86, S. 487.
[489] Zeitschrift für Nahrungsmittel-Untersuchung, Band 10, S. 104.
[490] Zeitschrift für physiologische Chemie, Band 9, S. 445.
[491] American Chemical Journal, Vol. 6, p. 289.
[492] Journal of the American Chemical Society, Vol. 18, p. 428.
[493] Journal de Pharmacie et de Chimie, 6e Série, Tome 4, p. 65.
[494] Contribution à l’Étude des Lactoses, Thèse pour le diplôme supérieure de Pharmacie, Paris, 1892. (Read Thibault instead of Thibonet.)
[495] Journal für praktische Chemie, Neue Folge, Band 15, S. 348.
[496] Zeitschrift für angewandte Chemie, 1896, S. 72.
[497] Chemisches Central-Blatt, 1892, Band 2, S. 1028.
[498] Vid. op. cit. supra, Band 21, S. 753.
[499] Vid. op. cit. 90, S. 86.
[500] Bulletin No. 13, Division of Chemistry, U. S. Department of Agriculture, pp. 29 et seq.
[501] Vid. op. cit. supra, pp. 73-75: Bulletin No. 46, Division of Chemistry, U. S. Department of Agriculture, p. 26.
[502] Benedikt and Lewkowitsch; Oils, Fats and Waxes, p. 490.
[503] Forsuchungs-Berichte über Lebensmittel, 1895, Band 2, S. 424; Chemiker-Zeitung Repertorium, 1896, Band 20, S. 15.
[504] Revue Internationale des Falsifications, Mai, 1893, p. 157.
[505] Chemiker-Zeitung, 1893, Band 17, S. 468.
[506] Zeitschrift für angewandte Chemie, 1896, S. 177.
[507] Vid. op. cit. 90, Aug. 26, 1894, S. 219; Le Stazioni Sperimentali Agrarie Italiane, 1893, pp. 25-77.
[508] Farmers’ Bulletin No. 12, U. S. Department of Agriculture.
[509] Bulletin de l’Association Belge des Chimistes, Tome 9, p. 279.
[510] Vid. op. cit. 101, p. 26.
[511] Vid. op. cit. supra, p. 27: Chemical News, Vol. 55, p. 49.
[512] Vid. op. cit. 111, p. 28.
[513] Vid. op. et. loc. cit. supra.
[514] Russell; Dairy Bacteriology.
[515] Woll; Dairy Calendar, p. 223.
[516] Van Slyke; Bulletin 82, New Series, New York Agricultural Experiment Station, p. 654.
[517] Babcock; Twelfth Annual Report Wisconsin Agricultural Experiment Station, p. 133.
[518] Woll; Dairy Calendar, 1895, p. 220.
[519] Bulletin No. 46, Division of Chemistry, U. S. Department of Agriculture, p. 37.
[520] Landwirtschaftliches Jahrbuch, 1872, part 1.
[521] Molkerei Zeitung, 1893, Nos. 20, 22.
[522] This work, Vol. 2, p. 204.
[523] Vid. op. cit. 120, p. 24.
[524] Milch Zeitung, 1895, Band 24, S. 729: Chemiker-Zeitung Repertorium, Band 19, S. 372.
[525] Chemiker-Zeitung, 1895, S. 554.
[526] Zeitschrift für analytische Chemie, Band 35, S. 497.
[527] Vid. op. cit. supra, S. 499.
[528] Vid. op. cit. supra, S. 502.
[529] Bulletin No. 13, Division of Chemistry, U. S. Department of Agriculture, pp. 118, 293.
[530] This work, Vol. 2, p. 204.
[531] Pflüger’s Archiv, Band 56, S. 558.
[532] Hoppe-Seyler’s Zeitschrift für physiologische Chemie, Band 22, S. 213.
[533] Bulletin de la Société Chimique de Paris, Tomes 15-16, p. 1126.
[534] American Chemical Journal, Vol. 8, p. 200: Bulletin 13, Division of Chemistry, U. S. Department of Agriculture, p. 120.
527. Classification.—In the preceding parts have been set forth the fundamental principles underlying the conduct of agricultural analysis and a résumé of the best practice of the art. The analyst, as a rule, will seldom be required to undertake investigations which are unnoticed in the preceding pages. Cases will arise, however, in which problems are presented which can not be solved by the rules already elucidated. In respect of the great classes of agricultural bodies, it will be observed that dairy products have already received special mention. In respect of foods and fodders in general, it is evident that they are chiefly composed of moisture, ash, carbohydrates, oils and proteid matters. The methods of identifying, separating and estimating these constituents have been fully set forth. It is not necessary, therefore, to study in this part the analytical processes which are applicable to cereals, cattle foods and other food products, further than is necessary to present in the most important cases a working résumé of principles and methods. There remain, however, certain products of importance which require some special modifications of treatment, and it is to these that the present part will be chiefly devoted. Among these are found tobacco, tea and coffee, fruits, fermented and distilled drinks and certain animal products. It is evident that an enumeration of all agricultural products, with a description of their methods of examination, would be impracticable in the available space and undesirable by reason of the repetition which would be required. In each case the analyst, in possession of the methods described, will be able to adapt the means at his disposal to the desired purpose to better advantage than any rigid directions could possibly secure. [Pg 542]
In respect of the analytical methods of determining the nutritive value of foods, they may be divided into chemical and physiological. The chemical methods embrace the thermal and artificial digestion investigations, and the physiological include those which are carried out with the help of the animal organisms. In the latter case the digestive process is checked by the analysis of the foods before ingestion and of the excreta of all kinds during and after digestion.
It is evident that a detailed description of this method should be looked for in works devoted to physiological chemistry.
528. General Analysis.—The cereals are prepared for analysis by grinding until the fragments pass a sieve having circular perforations half a millimeter in diameter. The moisture, ash, ether extract, proteids and carbohydrates are determined by some one of the processes already described in detail. In this country the methods of the Association of Official Agricultural Chemists are generally followed.[535] For convenience these methods are summarized below.
Moisture.—Dry from two to three grams of the fine-ground sample for five hours, at the temperature of boiling water, in a current of dry hydrogen. If the substance be held in a glass vessel, the latter should not be in contact with the boiling water.
Ash.—Char from two to three grams of the sample and burn to whiteness at the lowest possible red heat. If a white ash can not be obtained in this manner, exhaust the charred mass with water, collect the insoluble residue on a filter, burn it, add this ash to the residue from the evaporation of the aqueous extract and heat the whole to low redness until the ash is white.
Ether Extract.—Pure ether is prepared by washing the commercial article four or five times with water to free it of the chief part of the alcohol it contains. The residual water is mostly removed by treating the liquid with caustic soda or potash. Any residual alcohol or water is finally removed by the action of metallic sodium. The ether thus prepared is stoppered, after the evolution of hydrogen has ceased, [Pg 543] and is kept over metallic sodium. Immediately before use it should be distilled out of contact with moist air.
The residue from the determination of moisture, as described above, is extracted in an appropriate apparatus (39) with the pure ether for sixteen hours. The extract is dried to constant weight. The weight may be checked by drying and weighing the extraction tube and its contents before and after the operation.
Crude Proteids.—Proceed as in the method of determining nitrogen in the absence of nitrates and multiply the weight of nitrogen obtained by 6.25. This factor is a general one, but should not be rigidly applied. In each instance, according to the nature of the cereal, the appropriate factor, pointed out in paragraph 407 should be used, and the factor 6.25 be applied only in those cases where a special factor is not given. The factors for the common cereals are wheat 5.70, rye 5.62, oats 6.06, maize 6.22, barley 5.82 and flaxseed 5.62.
For separating the proteid matters consult paragraphs 392-410. In the case of wheat the methods of Teller may be consulted.[536]
Amid Nitrogen.—The albuminoid nitrogen is determined as directed in paragraph 203 of volume II. The difference between this number and that representing the total nitrogen gives the nitrogen as amids.
Fiber and Carbohydrates.—The methods of analysis are described in detail in Part Third.
529. Bread.—In general, the same processes are followed in bread analysis as are used with cereals and flours. In addition to the regular analytical processes, breads are to be examined for adulterants, bleaching and coloring matters, and for the purpose of determining the changes which have taken place in their nutrient constituents in the processes of fermentation and cooking.
Temperature of Baking.—The interior of a loaf during the process of baking does not attain the high temperature commonly supposed. This temperature is rarely found to be more than one degree above the boiling point of water.[537] In biscuits and other thin cakes, which become practically dry and which by reason of their thinness are the more readily penetrated by heat, the temperature may go as high as 110°.
Soluble Extract.—The quantity of matters both in flour and bread, soluble in cold water, is determined by extraction in the usual [Pg 544] way and drying the extract. Soluble albuminoids, sugars and mineral salts are extracted by this process. When possible, the operation should be conducted both on the bread and the flour from which it is made.
Color.—In baker’s parlance is found an apparent contradiction of terms, since it speaks of bread with “no color” when the loaf is dark brown, while a white loaf is said to have a high color. An ideal color for the interior of a loaf is a light cream tint, which is more desirable than a pure white.[538] The texture, odor and flavor of the loaf are also to be considered, but these are properties of more importance to the technical expert than to the analyst.
Quantity of Water.—It is not possible to set a rule of limitation in respect of the quantity of water a bread should hold. For full loaves, perhaps forty per cent is not too high a maximum, while some authors put it as low as thirty-four per cent. Some flours are capable of holding more water than others, and the loaf should have just enough water to impart to the slice of bread the requisite degree of softness and the proper texture. Most breads will have a content of water ranging from thirty to forty per cent. In biscuits and other thin cakes the moisture is much less in quantity.
Acidity.—The acidity of both bread and flour is determined by shaking ten grams of the sample with 200 cubic centimeters of distilled water for fifteen minutes, pouring the mass on a filter and titrating an aliquot part of the filtrate with tenth-normal alkali. The acidity is reckoned as lactic acid in the case of breads raised by fermentation.
Nature of Nitrogenous Compounds.—The methods of investigation are described in paragraphs 392-410.
530. Determination of Alum in Bread.—The presence of alum in bread may be detected by means of logwood. Five grams of fresh logwood chips are digested with 100 cubic centimeters of amyl alcohol. One cubic centimeter of this decoction and the same quantity of a saturated solution of ammonium carbonate are mixed with ten grams of flour and an equal quantity of water. With pure flour, a slight pink tint is [Pg 545] produced. In the presence of alum the color changes to a lavender or blue, which is persistent on heating.
The test may be varied by diluting five cubic centimeters of the reagents mentioned with ninety cubic centimeters of water and pouring the mixture over ten grams of the crumbled bread. After standing for five minutes, any residual liquid is poured off and the residue, washed once with a little water, is dried in a steam bath, when the blue color is developed if alum be present.[539]
531. Chemical Changes Produced by Baking.—Changes of a chemical nature, produced in bread by baking, are found chiefly in modifications of the starch and proteids. The starch is partly converted into dextrin and the albumins are coagulated. The changes in digestion coefficient are determined by the methods which follow. The fermentations which precede the baking are due to the usual decompositions of the carbohydrates under the influence of yeast germs.
532. General Principles.—The analyst, in examining the fibrous foods of cattle, is expected to determine moisture, ash, fiber and other carbohydrates, ether extract and albuminoid and amid nitrogen. If a more exhaustive study be required, the sugar and starch are separated from the other non-nitrogenous matters, the carbohydrate bodies yielding furfuraldehyd separately determined and the ash subjected to a quantitive analysis. The processes are conducted in harmony with the principles and methods of procedure fully set forth in the preceding pages.
Green fodders and grasses are easily dried and sampled by comminution in the shredder described on page 9, and roots by that shown on page 10. The moisture is determined by drying a small sample of the shredded mass, while the rest of it is dried, first at about 60° and finally at 100°, or a little above, ground to a fine powder and subjected to analysis by methods already described. The food values as obtained by analysis should be compared, when possible, with those secured by natural and artificial digestion. [Pg 546]
Ensilage is shredded and analyzed in precisely the same way, but in drying, the content of volatile acids formed during fermentation must be considered. In other words, the loss on drying ensilage at 100°, or slightly above, is due not only to the escape of water but also to the volatilization of the acetic acid, which is one of the final products of fermentation which the mass undergoes in the silo.
533. Organic Acids in Ensilage.—In the examination of ensilage, the organic acids which are present may be determined by the processes described in following paragraphs. The acetic acid, formed chiefly by fermentation, is conveniently determined by the method given for tobacco further on. Lactic acid is detected and estimated by expressing the juice from a sample of ensilage, removing the acetic acid by distillation, repeated once or twice, and treating the filtered residue with zinc carbonate in excess, filtering and determining the zinc lactate in the filtrate. The zinc is determined by the method described for evaporated apples and the lactic acid calculated from the weight of zinc found. Crystallized zinc lactate contains 18.18 per cent of water and 27.27 per cent of zinc oxid.[540]
534. Changes due to Fermentation in the Silo.—Silage differs from green fodder in having less starch and sugar, more acetic and lactic acids and alcohol and a higher proportion of amid to albuminoid nitrogen.[541] There is also a considerable loss of nitrogenous substances in ensilage, due probably to their conversion into ammonium acetate, which is lost on drying.
535. Alcohol in Ensilage.—The fermentation which takes place in the silo is not wholly of an alcoholic nature, as the development of lactic acid, noted above, clearly indicates. The alcohol which is formed may escape and but small quantities can be detected in the ripened product. So small is this quantity of alcohol that it appears to be useless to try to secure a quantitive estimation of it. Qualitively, it may be detected by collecting it in a distillate, which is neutralized or made slightly alkaline with soda or potash lye and redistilled. The greater part of the alcohol will be found in the first few cubic centimeters, which are made alkaline with potash lye and as [Pg 547] much iodin added as can be without giving a red tint to the solution. Any alcohol which is present will soon separate as iodoform.
536. Comparative Values of Fodder and Ensilage.—In judging of the comparative values of green and dry fodders for feeding purposes, it is necessary to secure representative samples in the green, quickly dried and ensilaged condition. It is quite certain that the greater part of the sugar contained in green fodders is lost both by natural curing and by placing in a silo. When well cured by the usual processes there is but little loss of nitrogenous matters, but in the silo this loss is of considerable magnitude, amounting in some instances to as much as thirty per cent.
The ideal way of preparing green fodders in order to preserve the maximum food value efficiently, is to shred them and dry rapidly by artificial heat, or in the sunlight, until they are in a condition which insures freedom from fermentation. In this condition, when placed in bales, under heavy pressure, the food constituents are preserved in the highest available form. The immense sugar content of the stalks of maize and sorghum could be preserved in this way almost indefinitely.
537. Names Of Meats.—The parts of the animal from which the meats are taken have received distinctive names, which serve to designate the parts of the carcass offered for sale. These names are not invariable and naturally are quite different in many markets. In this country there is some degree of uniformity among butchers in naming the meats from different parts. The names in scientific use for the parts of mutton, beef and pork are found in the accompanying illustrations.[542]
538. Sampling.—When possible the whole animal should constitute the sample. The relative weights of blood, intestinal organs, hide, hoofs, horns, bones and edible flesh are determined as accurately as possible. The general method of preparing samples of animal products is given in paragraph 5. [Pg 548]

Fig. 114.

Fig. 115.

Fig. 116.
Names of Cuts of Meat.
[Pg 549] The method of sampling employed by Atwater and Woods is essentially that just noted.[543] The sample, as received at the laboratory, is weighed, the flesh (edible portion) is then separated from the refuse (skin, bones etc.) and both portions weighed. There is always a slight loss in the separation, evidently due to evaporation and to small fragments of the tissues that adhere to the hands and to the implements used in preparing the sample. The perfect separation of the flesh from the other tissues is difficult, but the loss resulting from this is small. In sampling the material for analysis, it is finely chopped, either in a tray or in a sausage cutter, and in each case is well mixed.
539. Methods of Analysis.—The general methods for the analyses of food products are applicable to meats and animal products in general. In the separation of the nitrogenous constituents the methods described in paragraphs 411-414 are followed. It is not safe to estimate as proteids the total nitrogen multiplied by 6.25, since the flesh bases have much higher percentages of nitrogen than are found in proteid matters. As indicated in paragraph 280 the complete extraction of dried meats by ether is difficult of accomplishment. After a few hours it may be assumed that the total extract will represent the fat, although additional soluble matters are obtained by continuing the process. The heat producing power may be calculated from the analytical data secured. The methods which have been described in the preceding pages will be found sufficient for guidance in the examination of animal products, and the analyst will find them, when modified to suit particular cases, adapted to the isolation and estimation of proximate food principles.
The methods of analyses followed by Atwater and Woods are given below:[544]
Water and Water-Free Substance.—The drying is done in ordinary water ovens at a temperature of nominally 100°, but actually at 96° and 98°. For each analysis of animal tissues (flesh) one or more samples of from fifty to one hundred grams of the freshly chopped substance are weighed on a small plate, heated for from twenty-four to forty-eight [Pg 550] hours, cooled, allowed to stand in the open air for about twenty-four hours, weighed, ground, sifted through a sieve with circular holes one-half millimeter in diameter, bottled and set aside for analysis. In case of fat samples which cannot be worked through so fine a sieve, either a coarser sieve is used or the substance crushed as finely as practicable and bottled without sifting.
For the complete desiccation, about two grams of material are dried for three hours. It is extremely difficult to get an absolutely constant weight, though it is found that this is in most cases approximately attained in four hours.
Nitrogen, Protein, Albuminoids etc.—The nitrogen is determined in the partly dried substance by the method of Kjeldahl. The protein is calculated by multiplying the percentage of nitrogen by 6.25. The nitrogenous matters in meats and fish, i. e., in the materials which have practically no carbohydrates, are also estimated by subtracting the sum of ether extract and ash from the water-free substance, or the sum of water, ether extract and ash from the fresh substance, the remainder being taken as proteids, albuminoids etc., by difference. While this is not an absolutely correct measure of the total nitrogenous matter, it is doubtless more nearly so than the product of the nitrogen multiplied by 6.25.
Fat (Ether Extract).—The fat is extracted with ether in the usual manner. The point at which the extraction is complete is not always easy to determine. For the most part, the extraction is continued for such time as experience indicates to be sufficient, and then the flask is replaced by another and the extraction repeated until the new flask shows no increase in weight.
According to experience, the fat of many animal tissues is much more difficult to extract than that of most vegetable substances. In general, the greater the percentage of fat in a substance the more difficult is the removal of the last traces. Dried flesh is frequently so hard that the fineness of the material to be extracted seems to be a very important matter.
Ash.—Ash is determined by the method recommended by the Association of Official Agricultural Chemists. [Pg 551]
Food Value—Potential Energy.—The food materials are not necessarily burned in the calorimeter, but the fuel value of a pound of each of the foods, as given in the tables, is obtained by multiplying the number of hundredths of a pound of protein and of carbohydrates by 18.6 and the number of hundredths of a pound of fat by 42.2, and taking the sum of these three products as the number of calories of potential energy in the materials.
More reliable results are obtained by using the factors obtained by Stohmann; viz., 5731 calories for proteids, 9500 calories for common glycerids, 9231 calories for butter fat, 3746 calories for pentose sugars, 3749 calories for dextrose and levulose and 3953 calories for sucrose and milk sugar.[545]
540. Further Examination of Nitrogenous Bodies.—It is evident that both of the methods proposed above for the examination of the nitrogenous constituents of meats are unreliable. If the total nitrogen be determined and multiplied by 6.25 the product does not by any means represent the true quantity of nitrogenous matter since the flesh bases contain in some instances more than twenty-five per cent of nitrogen.
If, on the other hand, the water, ash and fat in a meat sample be determined and the sum of their per cents be subtracted from 100, the difference represents the nitrogenous bodies plus all undetermined matters and errors of analysis. The assumption that meats are free of carbohydrates is not tenable since glycogen is constantly found therein and in horse flesh in comparatively large amounts. In a thoroughly scientific analysis of meats, the nitrogenous bodies should be separated and determined by groups, according to the principles developed in paragraphs 411-414. This process requires a great amount of analytical work and in general it will be sufficient to make a cold water extract to secure the flesh bases and a hot water extract to secure the gelatin. The nitrogen is then determined in each of these portions separately. The nitrogen in the cold water extract is multiplied by four, in the hot water extract by six and in the residue by 6.25. The sum of these products represents approximately the total nitrogenous matter in the sample. [Pg 552]
Aqueous extracts containing nitrogen are easily prepared for moist combustion by placing them in the digestion flasks, connecting the latter with the vacuum service and evaporating the contents of the flask nearly to dryness. The sulfuric acid is then added and the nitrogen converted into ammonia and determined in the usual manner.
541. Fractional Analysis of Meats.—A better idea of the composition of a meat is obtained by separating its constituents into several groups by the action of different solvents. This method has been elaborated by Knorr.[546]
The separation of the meats in edible portion and waste and the determination of moisture and fat are conducted as already described. The residue from the fat extraction is exhausted with alcohol, and in the extract are found the nitrogenous bases kreatin, kreatinin, sarkin and xanthin, and urea, lactic, butyric, acetic and formic acids, glycogen and inosit. In the residue from the alcohol extraction, the proteid nitrogen is determined in a separate sample.
A separate portion of the sample is ground to a fine paste and repeatedly rubbed up with cold water, which is poured through a tared filter. When the extraction is complete, the filter and its contents are dried and the dry residue determined. This residue represents the nitrogenous constituents of the muscle fibers and their sheaths together with any other bodies insoluble in cold water. The filtrate from the cold water extraction is heated to boiling to precipitate the albuminous matters which are collected, dried and weighed, or the nitrogen therein determined and the albuminous matters calculated by multiplying by the usual factor. The filtrate from the coagulated albuminous bodies is evaporated to dryness and weighed. It consists essentially of the same materials as the alcoholic extract mentioned above. The ash and nitrogen in the aqueous extract are also determined.
The mean content of the edible parts of common meats, expressed as per cents in groups as mentioned, follow: [Pg 553]
| Per cent. | |
| Water | 73.11 |
| Ash | 1.18 |
| Total soluble matter | 26.89 |
| Phosphoric acid | 0.49 |
| Per cent. |
|
| Proteids insoluble in cold water | 13.76 |
| Of which coagulable by heat | 2.24 |
| Cold water extract | 3.56 |
| Ash in water extract | 1.09 |
| Of which phosphoric acid | 0.38 |
| Per cent. |
|
| Fat | 4.93 |
| Alcohol extract | 3.03 |
| Proteids in residue from alcohol | 17.88 |
| Total nitrogen in sample | 3.37 |
542. Estimation of Starch in Sausages.—Starchy substances are sometimes added to sausages for the purpose of increasing their weight. The presence of starch in a sausage is easily detected by iodin. The quantity may be determined by the following process:[547]
The principle of the process is based upon the observation that while starch is easily soluble in an aqueous solution of the alkalies, it is insoluble in an alcoholic solution thereof. The chief constituents of meat, viz., fat and proteid matters, on the other hand, are readily soluble in an alcoholic solution of potash or soda. This renders the separation of the starch easy. The sample is warmed on a water bath with a considerable excess of an eight per cent solution of potassium hydroxid in alcohol whereby the fat and flesh are quickly dissolved. The starch and other carbohydrate bodies, remain in an undissolved state. In order to prevent the gelatinizing of the soap which is formed, the mass is diluted with warm alcohol, the insoluble residue collected upon a filter and washed with alcohol until the alkaline reaction disappears. The residue is then treated with aqueous potassium hydroxid solution, whereby the starch is brought into solution and, after filtration, is treated with alcohol until it is all precipitated. The precipitated starch is collected upon a filter, washed with alcohol and finally with ether, dried and weighed. Starch [Pg 554] prepared in this way contains a considerable quantity of potash, the amount of which can be determined by incineration. In order to avoid this trouble, the starch, after separation in the first instance as above mentioned and solution in aqueous potassium hydroxid, is precipitated on the addition of enough acetic to render the solution slightly acid. The precipitated starch, in this instance, is practically free of potash, since potassium acetate is soluble in alcohol.
543. Detection of Horse Flesh.—Since horse flesh has become an important article of human food and is often sold as beef and sausage, a method of distinguishing it is desirable. The comparative anatomist is able to detect horse flesh when accompanied by its bones, or in portions sufficiently large for the identification of muscular characteristics. It is well known that horse flesh contains a much higher percentage of glycogen than is found in other edible meats. Niebel has based a method of detecting horse flesh upon this fact, the glycogen being converted into dextrose and determined in the usual way. Whenever the percentage of reducing sugars in the dry fat-free flesh exceeds one per cent, Niebel infers that the sample under examination is horse flesh.[548]
The reaction for horse flesh, proposed by Bräutigam and Edelmann, is preferred by Baumert. In this test about fifty grams of the flesh are boiled for an hour with 200 cubic centimeters of water, the filtered bouillon evaporated to about half its volume, treated with dilute nitric acid and the clear filtrate covered with iodin water. Horse flesh, by reason of its high glycogen content, produces a burgundy red zone at the points of contact of the two liquids. In the case of sausages, if starch have been added, a blue zone is produced, and if dextrin be present, a red zone, both of which obscure the glycogen reaction. The starch is easily removed by treating the bouillon with glacial acetic acid. No method is at present known for separating dextrin from glycogen. The detection of horse flesh is a matter of considerable importance to agriculture as well as to the consumers, especially of sausages. A considerable quantity of horse flesh is annually sent to the market, little of which presumably is sold under [Pg 555] its own name. As a cheap substitute for beef and pork in sausages, its use must be regarded as fraudulent, although no objection can be urged against its sale when offered under its own name.[549]
544. Artificial Digestion.—The nutrient values of cereals and other foods are determined both by chemical analysis and by digestion experiments. The heat forming properties of foods are disclosed by combustion in a calorimeter, but the quantity of heat produced is not in every case a guide to the ascertainment of the nutritive value. This is more certainly shown, especially in the case of proteid bodies, by the action of the natural digestive ferments.
It is probable that the digestion, which is secured by the action of these ferments without the digestive organs, is not always the same as the natural process, but when the conditions which prevail in natural digestion are imitated as closely as possible the effects produced can be considered as approximately those of the alimentary canal in healthy action.
Three classes of ferments are active in artificial digestion, viz., amylolytic ferments, serving to hydrolyze starch and sugars and to convert them into dextrose, maltose and levulose, aliphalytic ferments, which decompose the glycerids and proteolytic ferments, which act on the nitrogenous constituents of foods. When these ferments are made to act on foods under proper conditions of acidity and temperature, artificial digestion ensues, and by the measurement of the extent of the action an approximate estimate of their digestibility can be secured. In artificial digestion, the temperature should be kept near that of the body, viz., at about 40°.
The soluble ferments which are active in the digestion of foods, as has been intimated, comprise three great classes. Among the first class, viz., the amylolytic ferments, are included not only those which convert starch into dextrose, but also those which cause the hydrolysis of sugars in general. Among these may be mentioned ptyalin, invertase, trehalase, maltase, lactase, diastase, inulase, pectase and cyto-hydrolytic ferments which act upon the celluloses and other fibers. [Pg 556]
Among the aliphalytic ferments, in addition to those which act also upon proteid matter, may be mentioned a special one, lipase.
In the third class of ferments are found pepsin, trypsin or pancreatin and papain.
For the latest information in regard to the nature of the soluble ferments and their nomenclature, the work of Bourquelot may be consulted.[550]
545. Amylytic Ferments.—A very active ferment of this kind is found in the saliva. Saliva may be easily collected from school boys, who will be found willing to engage in its production if supplied with a chewing gum. A gum free of sugar is to be used, or if the chewing gum of commerce is employed, the saliva should not be collected until the sugar has disappeared. A dozen boys with vigorous chewing will soon provide a sufficient quantity of saliva for practical use. The amylolytic digestion is conducted in the apparatus hereinafter described for digestion with pepsin and pancreatin. The starch or sugar in fine powder is mixed with ten parts of water and one part of saliva and kept at about 37°.5 for a definite time. The product is then examined for starch, sucrose, maltose, dextrose, dextrin and levulose by the processes already described. In natural digestion the hydrolysis of the carbohydrates is not completed in the mouth. The action of the ferment is somewhat diminished in the stomach, but not perhaps until half an hour after eating. The dilute hydrochloric acid in the stomach, which accumulates some time after eating, is not active in this hydrolysis. On the contrary the amylolytic ferment of the saliva is somewhat enfeebled by the presence of an acid. The active principle of the saliva is ptyalin.
The diastatic hydrolysis of starch has already been described (179). It is best secured at a somewhat higher temperature than that of the human stomach.
546. Aliphalytic Ferments.—In the hydrolysis of glycerids in the process of digestion the fat acids and glycerol are set free. Whether the glycerids be completely hydrolyzed before absorption is not definitely known. In certain cases where large quantities of oil have [Pg 557] been exhibited for remedial purposes, the fat acids and soaps have been found in spherical masses in the dejecta[551] and have been mistaken for gall stones.
The fat which enters the chyle appears to be mostly unchanged, except that it is emulsified.[552] The aliphalytic ferment can be prepared from the fresh pancreas, preferably from animals that have not been fed for forty hours before killing. It is important to prepare the ferment entirely free of any trace of acid. The fresh glands are rubbed to a fine paste with powdered glass and extracted for four days with pure glycerol, to which one part of one per cent soda solution has been added. The filtered liquor contains aliphalytic, proteolytic and amylytic ferments, and is employed for saponification by shaking with the fat to form an emulsion and keeping the mixture, with occasional shaking, at a temperature of from 40° to 60°. The free acids can be titrated or separated from the unsaponified fats by solution in alcohol.[553]
Heretofore it has not been possible to separate a pure aliphalytic ferment from any of the digestive glands. The digestion of carbohydrates and that of fats are intimately associated, and these two classes of foods seem to play nearly the same rôle in the animal economy.
The aliphalytic ferments, prepared from the fresh pancreas, act also on the glucosids and other ester-like carbohydrate bodies. Since the fats may be regarded as ethers, the double action indicates the similarity of composition in the two classes of bodies.[554] The aliphalytic ferments exist also in plants and have been isolated from rape seed.[555]
547. Proteolytic Ferments.—The most important process in artificial digestion is the one relating to the action of the ferments on proteid matters. The hydrolysis of fats and carbohydrates by natural ferments takes place best in an alkaline medium, while in the case of proteids when pepsin is used an acid medium is preferred. Since the acidity of the stomach is due chiefly to hydrochloric, that acid is employed in artificial digestion. The hydrolyte used is uniformly the natural ferment of the gastric secretions, viz., pepsin; but this is often followed by the pancreatic ferment, (pancreatin, trypsin) [Pg 558] in an alkaline medium. During the digestion, the proteids are changed into peptones, and the measurement of this change determines the degree of digestion. The total proteid matter is determined in the sample, and after the digestion is completed, the soluble peptones are removed by washing and the residual insoluble proteid matter determined by moist combustion. The difference in the two determinations shows the quantity of proteid matter digested. The investigations of Kühn on the digestion of proteids may be profitably consulted.[556] For a summary of digestion experiments in this country the résumé prepared by Gordon may be consulted.[557] The method followed in this laboratory is fully described by Bigelow and Hamilton.[558]
548. Ferments Employed.—Both the pepsins of commerce and those prepared directly from the stomachs of pigs may be used. The commercial scale pepsin is found, as a rule, entirely satisfactory, and more uniform results are secured by its use than from pepsin solutions made from time to time from pig stomachs. In the preparation of the pepsin solution one gram of the best scale pepsin is dissolved in one liter of 0.33 per cent hydrochloric acid. Two grams of the sample of food products, in fine powder, are suspended in 100 cubic centimeters of the solution and kept, with frequent shaking, at a temperature of 40° for twelve hours. The contents of the flask are poured on a wet filter, the residue on the filter well washed with water not above 40°, the filter paper and its contents transferred to a kjeldahl flask and the residual nitrogen determined and multiplied by 6.25 to get the undigested proteid matter. A large number of digestions can be conducted at once in a bath shown in Fig. 117.[559] The quantity of water in the bath should be as large as possible.
549. Digestion in Pepsin and Pancreatin.—The digestion of the proteids is not as a rule wholly accomplished by the stomach juices, and, therefore, in order to secure in artificial digestion results approximating those produced in the living organism, it is necessary to follow the treatment with pepsin by a similar one with the pancreas [Pg 559] juices. The method employed in this laboratory is essentially that of Stutzer modified by Wilson.[560]

Fig. 117. Bath for Artificial Digestion.
[Pg 560] The residue from the pepsin digestion, after washing, is treated for six hours at near 40° with 100 cubic centimeters of pancreas solution, prepared as follows:
Free the pancreas of a healthy steer of fat, pass it through a sausage grinder, rub one kilogram in a mortar with fine sand and allow to stand for a day or longer. Add three liters of lime water, one of glycerol, of 1.23 specific gravity, and a little chloroform and set aside for six days. Separate the liquor by pressure in a bag and filter it through paper. Before using, mix a quarter of a liter of the filtrate with three-quarters of a liter of water and five grams of dry sodium carbonate, or its equivalent crystallized, heat from 38° to 40° for two hours and filter.[561] In order to avoid the trouble of preparing the pancreas solution pure active pancreatin may be used.[562] One and a half grams of pure pancreatin and three grams of sodium carbonate are dissolved in one liter of water and 100 cubic centimeters of this solution are used for each two grams of the sample. In all cases where commercial pepsin and pancreatin are used, their activity should be tested with bodies such as boiled whites of eggs, whose coefficient of digestibility is well known and those samples be rejected which do not prove to have the required activity.[563]
550. Digestion in Pancreas Extract.—In order to save the time required for successive digestions in pepsin and pancreatin Niebling has proposed to make the digestion in the pancreas extract alone.[564] This process and also a slight modification of it have been used with success by Bigelow and McElroy.[565] Two grams of the sample are washed with ether and placed in a digestion flask with 100 cubic centimeters of two-tenths per cent hydrochloric acid. The contents of the flask are boiled for fifteen minutes, cooled, and made slightly alkaline with sodium carbonate. One hundred cubic centimeters of the unfiltered pancreas solution, prepared as directed above, are added and the digestion continued at 40° for six hours. The residue is thrown on a filter, washed, and the nitrogen determined. The method is simplified by the substitution of active commercial pancreatin for pancreas extract. The solution of the ferment is made of the same strength as is specified above. [Pg 561]
551. Artificial Digestion of Cheese.—The artificial digestion of cheese is conducted by Stutzer as follows:[566]
The digestive liquor is prepared from the fresh stomachs of pigs by cutting them into fine pieces and mixing with five liters of water and 100 cubic centimeters of hydrochloric acid for each stomach. To prevent decomposition, two and a half grams of thymol, previously dissolved in alcohol, are added to each 600 cubic centimeters of the mixture. The mixture is allowed to stand for a day with occasional shaking, poured into a flannel bag and the liquid portion allowed to drain without pressing. The liquor obtained in this way is filtered, first through coarse and then through fine paper, and when thus prepared will keep several months without change. It is advisable to determine the content of hydrochloric acid in the liquor by titration and this content should be two-tenths of a per cent. The cheese to be digested is mixed with sand as previously described, freed of fat by extraction with ether, and a quantity corresponding to five grams of cheese placed in a beaker, covered with half a liter of the digestive liquor and kept at a temperature of 40° for forty-eight hours. At intervals of two hours the flasks are well shaken and five cubic centimeters of a ten per cent solution of hydrochloric acid added and this treatment continued until the quantity of hydrochloric acid amounts to one per cent. After the digestion is finished, the contents of the beaker are thrown on a filter, washed with water and the nitrogen determined in the usual way in the residue. By allowing the pepsin solution to act for two days as described above, the subsequent digestion with pancreas solution is superfluous.
552. Suggestions Regarding Manipulation.—The filter papers should be as quick working as possible to secure the separation of all undissolved particles. They should be of sufficient size to hold the whole contents of the digestion flask at once, since if allowed to become empty and partially dry, filtration is greatly impeded. The residue should be dried at once if not submitted immediately to moist combustion. After drying, the determination of the nitrogen can be made at any convenient time. Beaker flasks, i. e., lip erlenmeyers [Pg 562] with a wide mouth are most convenient for holding the materials during digestion. The flasks are most conveniently held by a crossed rubber band attached at either end to pins in the wooden slats extending across the digestive bath. The bath should be suspended by cords from supports on the ceiling and a gentle rotatory motion imparted to it resembling the peristaltic action attending natural digestion.
553. Natural Digestion.—The digestion of foods by natural processes is determined chiefly by the classes of ferments already noted. The principle underlying digestive experiments with the animal organism may be stated as follows: A given weight of food of known composition is fed to a healthy animal under the conditions of careful control and preparation already mentioned. The solid dejecta of the animal during a given period are collected and weighed daily, being received directly from the animal in an appropriate bag, safely secured, as is shown in the accompanying figure. The dejecta are weighed, dried, ground to a fine powder, mixed and a representative part analyzed. The difference between the solid bodies in the dejecta and those given in the food during the period of experiment represents those nutrients which have been digested and absorbed during the passage of the food through the alimentary canal. The urine, containing solid bodies representing the waste of the animal organism, does not require to be analyzed for the simple control of digestive activity outlined above. In a complete determination of this kind the exhalations from the surface of the body and from the lungs are also determined. In the latter case the human animal is selected for the experiment; in the former it is more convenient to employ the lower animals, such as the sheep and cow.
The arrangement of the stalls and of the apparatus for collecting the excreta should be such as is both convenient and effective.[567]
The method of constructing a bag for attachment to a sheep is shown in Fig. 118. It is made according to the directions given by Gay, of heavy cloth and in such a way as to fit closely the posterior parts of the animal.[568] When attached, its appearance is shown in Fig. 119. [Pg 563]

Fig. 118.—Bag for
Collecting Feces.

Fig. 119.—Fecal Bag Attachment.
Healthy animals in the prime of life are used, and the feeding experiments are conducted with as large a number of animals as possible, in order to eliminate the effects of idiosyncrasy. The food used is previously prepared in abundant quantity and its composition determined by the analysis of an average sample.
The feeding period is divided into two parts. In the first part the animal is fed for a few days with the selected food until it is certain that all the excreta are derived from the nutrients used. In the second part the same food is continued and the excreta collected, weighed, the moisture determined, and the total weight of the water-free excreta ascertained. The first part should be of at least seven and the second of at least five days duration. The urine and dung are analyzed separately. Males are preferred for the digestion experiments because of the greater ease of collecting the urine and feces without mixing. For ordinary purposes the feces only are collected. The methods of analysis do not differ from those described for the determination of the usual ingredients of a food.
Example.—The following data taken from the results of digestive [Pg 564] experiments, obtained at the Maine Station, will illustrate the method of comparing the composition of the food with that of the feces and of determining the degree of digestion which the proteids and other constituents of the food have undergone.
Composition of Maize Fodder and of Feces
Therefrom after Feeding to Sheep.
| Before Drying. | ||||||
|---|---|---|---|---|---|---|
| Food | Water, per cent. |
Ash, per cent. |
Proteid, per cent. |
Fiber, per cent. |
Fat, per cent. |
Undetermined, per cent. |
| Sweet maize | 83.85 | 1.13 | 2.18 | 4.14 | 0.62 | 8.08 |
| Feces | 72.01 | ... | ... | ... | ... | ... |
| Dry. |
||||||
| Food | Ash, per cent. |
Proteid, per cent. |
Fiber, per cent. |
Fat, per cent. |
Undetermined, per cent. |
|
| Sweet maize | 7.01 | 13.52 | 25.63 | 3.86 | 49.98 | |
| Feces | 14.42 | 17.52 | 19.34 | 2.68 | 46.04 | |
| Daily Weights. |
||||||
| Food | Green, grams. |
Dry, grams. |
||||
| Sweet maize | 2521 | 407 | ||||
| Feces | 445 | 125 | ||||
| Per Cent Digested. |
||||||
| Food | Ash, | Proteid, | Fiber, | Undetermined, | Fat, | |
| Sweet maize | 37.0 | 60.2 | 76.9 | 71.8 | 78.3 | |
In the above instance it is seen that the coefficient of digestibility extended from 37.0 per cent in the case of the mineral components of the food, to 78.3 per cent in the case of the fats. These data are taken only from the results obtained from a single sheep and one article of food. The mean data secured from two animals and three kinds of maize fodder show the following per cents of digestibility: Ash 39.4, proteid 61.8, fiber 76.7, undetermined matters 72.1, fat 76.4. The undetermined matters are those usually known as nitrogen free extract and composed chiefly of pentosans and other carbohydrates.[569]
554. Natural Digestibility of Pentosans.—The digestibility of pentosan bodies in foods under the influence of natural ferments has been investigated by Lindsey and Holland.[570] The feeding and collection of the feces is carried on as described above and the relative proportions of pentosan bodies in the foods and feces [Pg 565] determined by estimating the furfuraldehyd as prescribed in paragraph 150.[571]
555. Methods of Examination.—In general the methods of examination are the same as those applied in the study of fresh meats. The contents of water, salt and other preservatives, fat and nitrogenous matters are of most importance. When not already in a fine state, the preserved meats are run through meat cutters until reduced to a fine pulp. Most potted meats are already in a state of subdivision well suited to analytical work. The composition of preserved meats has been thoroughly studied in this laboratory by Davis.[572]
556. Estimation Of Fat.—Attention has already been called to the difficulty of extracting the fat from meats by ether or other solvents.[573] In preserved meats, as well as in fresh, it is preferable to adopt some method which will permit of the decomposition of the other organic matters and the separation of the fat in a free state. The most promising methods are those employed in milk analyses for the solution of nitrogenous matters. Sulfuric or hydrochloric acid may be used for this purpose, preference being given to sulfuric. The separated fats may be taken up with ether or separated by centrifugal action. A method of this kind for preserved meats, suggested by Hefelmann, is described below.
About six grams of the moist preserved meat are placed in a calibrated test tube and dissolved in twenty-five cubic centimeters of fuming hydrochloric acid. The tube is placed in a water bath, quickly heated to boiling and kept at that temperature for half an hour. About twenty cubic centimeters of cold water are added and the temperature lowered to 30°, then twenty cubic centimeters of ether and the tube gently shaken to promote the solution of the fat. When the ether layer has separated, its volume is read and an aliquot part removed by means of a pipette, dried and weighed. The separation of the ethereal solution is greatly promoted by whirling.
The mean proportions of the ingredients of preserved meats are about as follows: [Pg 566]
| Per cent. | |
| Water | 67.0 |
| Dry matter | 33.0 |
| Of which | |
| Nitrogenous bodies | 19.0 |
| Fats | 10.5 |
| Ash and undetermined | 3.5 |
557. Meat Preservatives.—Various bodies are used to give taste and color to preserved meats and to preserve them from fermentation. The most important of these bodies are common salt, potassium and sodium nitrates, sulfurous, boric, benzoic and salicylic acids, formaldehyd, saccharin and hydronaphthol. A thorough study of the methods of detecting and isolating these bodies has been made in this laboratory by Davis and the results are yet to be published as a part of Bulletin 13.
558. Nutritive Value of Foods.—The value of a food as a nutrient depends on the amount of heat it gives on combustion in the tissues of the body, i. e. oxidation, and in its fitness to nourish the tissues of the body, to promote growth and repair waste. The foods which supply heat to the body are organic in their nature and are typically represented by fats and carbohydrates. The foods which promote growth and supply waste are not only those which preeminently supply heat, but also include the inorganic bodies and organic nitrogenous matters represented typically by the proteids. It is not proper to say that one class of food is definitely devoted to heat forming and another to tissue building, inasmuch as the same substance may play an important rôle in both directions. As heat formers, carbohydrates and proteids have an almost equal value, as measured by combustion in oxygen, while fat has a double value for this purpose. The assumption that combustion in oxygen forms a just criterion for determining the value of a food must not be taken too literally. There are only a few bodies of the vast number which burn in oxygen that are capable of assimilation and oxidation by the animal organism. Only those parts of the food that become soluble and assimilable under the action of the digestive ferments, take part in nutrition and the [Pg 567] percentage of food materials digested varies within wide limits but rarely approaches 100. It may be safely said that less than two-thirds of the total food materials ingested are dissolved, absorbed, decomposed and assimilated in the animal system. We have no means of knowing how far the decomposition (oxidation) extends before assimilation, and therefore no theoretical means of calculating the quantity of heat which is produced during the progress of digestion. The vital thermostat is far more delicate than any mechanical contrivance for regulating temperature and the quantity of food, in a state of health, converted into heat, is just sufficient to maintain the temperature of the body at a normal degree. Any excess of heat produced, as by violent muscular exertion, is dissipated through the lungs, the perspiration and other secretions of the body.
Pure cellulose or undigestible fiber, when burned in oxygen, will give a thermal value approximating that of sugar, but no illustration is required to show that when taken into the system the bodily heat afforded by it is insignificant in quantity.
Thermal values, therefore, have little comparative usefulness in determining nutritive worth, except when applied to foods of approximately the same digestive coefficient.
559. Comparative Value of Food Constituents.—It has already been noted that, judged by combustion in oxygen, carbohydrates and proteids have about half the thermal value possessed by fats. Commercially, the values of foods depend in a far greater degree on their flavor and cooking qualities than upon the amount of nutrition they contain. Butter fat, which is scarcely more nutritious than tallow, is worth twice as much in the market, while the prices paid for vegetables and fruits are not based to any great extent on their food properties.[574] In cereals, especially in wheat, the quantity of fat is relatively small, and starch is the preponderating element. In meats, carbohydrates are practically eliminated and fats and proteids are the predominating constituents.
In the markets, fats and proteids command far higher prices than sugars and starches. The relative commercial food value of a cereal may be roughly approximated by multiplying the percentages of fat and protein [Pg 568] by two and a half and adding the products to the percentage of carbohydrates less insoluble fiber. This method was adopted in valuing the cereals at the World’s Columbian Exposition.[575]
560. Nutritive Ratio.—In solid foods the nutritive ratio is that existing between the percentage of proteids and that of carbohydrates, increased by multiplying the fat by two and a half and adding the product. In a cereal containing twelve per cent of protein, seventy-two of carbohydrates, exclusive of fiber, and three of fat, the ratio is 12: 72 + 3 × 2.5 = 6.5. Instead of calculating the nutritive ratio directly from the data obtained by analysis, it may be reckoned from the per cents of the three substances in the sample multiplied by their digestive coefficient. Since the relative amounts of proteids, fats and carbohydrates digested do not greatly differ, the numerical expression of the nutritive ratio is nearly the same when obtained by each of these methods of calculation.
Where the proportion of protein is relatively large the ratio is called narrow, 1: 4 ... 6. When the proportion of protein is relatively small the ratio is called broad 1: 8 ... 12. In feeding, the nutritive ratio is varied in harmony with the purpose in view, a narrow ratio favoring the development of muscular energy, and a wide one promoting the deposition of fat and the development of heat. These principles guide the scientific farmer in mixing rations for his stock, the work horses receiving a comparatively narrow and the beeves a relatively wide ratio in their food.
561. Calorimetric Analyses of Foods.—The general principles of calorimetry have been already noticed. The theoretical and chemical relations of calorimetry have been fully discussed by Berthelot, Thomsen, Ostwald and Muir.[576] In the analyses of foods the values as determined by calculation or combustion are of importance in determining the nutritive relations.
Atwater has presented a résumé of the history and importance of the calorimetric investigations of foods to which the analyst is referred.[577]
In the computation of food values the percentages of proteids, carbohydrates and fats are determined and the required data obtained by [Pg 569] applying the factors 4100, 5500 and 9300 calories for one gram of carbohydrates, proteids and fats respectively.
For most purposes the computed values are sufficient, but it is well to check them from time to time by actual combustions in a calorimeter.
562. Combustion in Oxygen.—The author made a series of combustions of carbonaceous materials in oxygen at the laboratory of Purdue University in 1877, the ignition being secured by a platinum wire rendered incandescent by the electric current. The data obtained were unsatisfactory on account of the crudeness of the apparatus. The discovery of the process of burning the samples in oxygen at a high pressure has made it possible to get expressions of thermal data which while not yet perfect, possess a working degree of accuracy. The best form of bomb calorimeter heretofore employed is that of Hempel, as modified by Atwater and Woods.[578]
A section of this calorimeter, with all the parts in place, is shown in Fig. 120.
In the figure the steel cylinder A, about 12.5 centimeters deep and 6.2 in diameter, represents the chamber in which the combustion takes place. Its walls are about half a centimeter thick and it weighs about three kilograms. It is closed, when all the parts are ready and the sample in place, by the collar C, which is secured gas tight by means of a powerful spanner. The cover is provided with a neck D carrying a screw E and a valve screw F. In the neck D, where the bottom of the cylinder screw E rests, is a shoulder fitted with a lead washer. Through G the oxygen used for combustion is introduced. The upper edge of the cylinder A is beveled and fits into a groove in the cover B, carrying a soft metal washer. To facilitate the screwing on of the cover, ball bearings KK, made of hard steel, are introduced between the collar and the cover. The platinum wires H and I support the platinum crucible holding the combustible bodies which are ignited by raising the spiral iron wire connecting them to the temperature of fusion by an electric current. The combustion apparatus when charged is immersed in a metal cylinder M, containing water and resting on small cylinders of cork. The water is [Pg 570] stirred by the apparatus LL. The cylinder M is contained in two large concentric cylinders, N, O, made of non-conducting materials and covered with disks of hard rubber. The space between O and N may be filled with water. The temperature is measured by the thermometer P, graduated to hundredths of a degree and the reading is best accomplished by means of a cathetometer.

Fig. 120. Hempel and Atwater’s
Calorimeter.
563. The Williams Calorimeter.—The calorimeter bomb has been improved by Williams by making it of aluminum bronze of a spheroidal shape. The interior of the bomb is plated with gold. By an ingenious arrangement of contacts the firing is secured by means of a permanently insulated electrode fixed in the side of the bomb. The calorimetric water, as well as that in the insulating vessel, is stirred by means of an electrical screw so regulated as to produce no appreciable degree of heat mechanically. The combustion is started by fusing a fine platinum wire of definite length and thickness by means of an electric current. The heat value of this fusion is determined and the calories produced deducted from the total calories of the combustion. The valve admitting [Pg 571] the oxygen is sealed automatically on breaking connection with the oxygen cylinder. The effluent gases, at the end of the combustion, may be withdrawn through an alkaline solution and any nitric acid therein thus be fixed and determined.[579]
564. Manipulation and Calculation.—The material to be burned is conveniently prepared by pressing it into tablets. The oxygen is supplied from cylinders, of which two should be used, one at a pressure of more than twenty atmospheres. By this arrangement a pump is not required.
In practical use, a known weight of the substance to be burned is placed in the platinum capsule, the cover of the bomb screwed on, after all adjustments have been made, and the apparatus immersed in the water contained in M, which should be about 2° below room temperature. All the covers are placed in position and the temperature, of the water in M begins to rise. Readings of the thermometer are taken at intervals of about one minute for six minutes, at which time the temperature of the bomb and calorimetric water may be regarded as sensibly the same. The electric current is turned on, the iron wire at once melts, ignites the substance and the combustion rapidly takes place. In the case of bodies which do not burn readily Atwater adds to them some naphthalene, the thermal value of which is previously determined. The calories due to the combustion of the added naphthalene are deducted from the total calories obtained.
The temperature of the water in M rises rapidly at first, and readings are made at intervals of one minute for five minutes, and then again after ten minutes. The first of the initial readings, the one at the moment of turning on the current, and the last one mentioned above are the data from which the correction, made necessary by the influence of the temperature of the room, is calculated by the following formulas.[580]
The preliminary readings of the thermometer at one minute intervals are represented by t₁, t₂, t₃ ... tₙ₁. The last observation tₙ₁ is taken as the beginning temperature of the combustion and is represented in the formulas for calculations by Θ₁. The readings after combustion are also made at intervals of one minute, and are designated by Θ₂, Θ₃ ... Θₙ. The readings are continued until there is no observed change between the last two. Generally this is secured by five or six readings. [Pg 572]
The third period of observations begins with the last reading Θₙ, which in the next series is represented by tʹ₁, tʹ₂ ... tʹₙ₂.
In order to make the formulas less cumbersome let
| tₙ₁ - t₁ | = v, |
| n₁ - 1 |
| tʹₙ₁ - tʹ₁ | = vʹ, |
| n₂ - 1 |
| t₁ + t₂ + t₃ ... tₙ₁ | = t, |
| n₁ |
| and | tʹ₁ + tʹ₂ + tʹ₃ ... tʹₙ₂ | = tʹ. |
| n₂ |
The correction to be made to the difference between Θₙ - Θ₁ for the influence of the outside temperature is determined by the formula of Regnault-Pfaundler, which is as follows:
| ∑ Δt = | v - vʹ | ( | ⁿ⁻¹ | ∑ | Θr + | Θₙ + Θ₁ | - nt ) - (n - 1)v, |
| tʹ - t | ₁ | 2 |
| n-1 | |
| in which ∑ | Θr |
| 1 |
is calculated from the observation of the thermometer Θ₁, Θ₂ etc., made immediately after the combustion. It is equal to the sum of observations Θ₁, Θ₂ etc., increased by an arbitrary factor equivalent to (Θ₂ - Θ₁)/9, which is made necessary by reason of the irregularity of the temperature increase during the first minute after combustion, the mean temperature during that minute being somewhat higher than the mean of the temperatures at the commencement and end of that time.
The quantity of heat formed by the combustion of the iron wire used for igniting the sample is to be deducted from the total heat produced. This correction may be determined once for all, the weight of the iron wire used being noted and that of any unburned portion being ascertained after the combustion.
Ten milligrams of iron, on complete combustion, will give sixteen calories.
In the combustion of substances containing nitrogen, or in case the free nitrogen of the air be not wholly expelled from the apparatus before the burning, nitric acid is formed which is dissolved by the water produced. [Pg 573]
The heat produced by the solution of nitric acid in water is 14.3 calories per gram molecule. The quantity of nitric acid formed is determined by titration and a corresponding reduction made in the total calculated calories.
In the titration of nitric acid it is advisable to make use of an alkaline solution, of which one liter is equivalent to 4.406 grams of nitric acid. One cubic centimeter of the reagent is equivalent to a quantity of nitric acid represented by one calorie.
Since the materials of which the bomb is composed have a specific heat different from that of water, it is necessary to compute the water thermal value of each apparatus.
The hydrothermal equivalent of the whole apparatus is most simply determined by immersing it at a given temperature in water of a different temperature.[581] With small apparatus this method is quite sufficient, but there are many difficulties attending its application to large systems weighing several kilograms. In these cases the hydrothermal equivalent may be calculated from the specific heats of the various components of the apparatus.
In calculating these values the specific heats of the various components of the apparatus are as follows:
| Brass | 0.093 |
| Steel | 0.1097 |
| Platinum | 0.0324 |
| Copper | 0.09245 |
| Lead | 0.0315 |
| Oxygen | 0.2389 |
| Glass | 0.190 |
| Mercury | 0.0332 |
| Hard rubber | 0.33125 |
Example.—It is required to calculate the hydrothermal value of a calorimeter composed of the following substances:
| Hydrothermal value. |
||
| Steel bomb and cover, 2850 grams × 0.1097 | 312.65 | grams. |
| Platinum lining, capsule and wires, 120 grams × 0.0324 | 3.89 | ” |
| Lead washer, 100 grams × 0.0315 | 3.15 | ” |
| Brass outer cylinder, 500 grams × 0.093 | 46.50 | ” |
| Mercury in thermometer, 10 grams × 0.0332 | 0.33 | ” |
| Glass (part of thermometer in water), 10 grams × 0.19 | 1.90 | ” |
| Brass stirring apparatus (part in water), 100 grams × 0.093 | 9.30 | ” |
| Total water value of system | 377.72 | ” |
[Pg 574] When a bomb of 300 cubic centimeters capacity is filled with oxygen at a pressure of twenty-four atmospheres it will hold about ten grams of the gas, equivalent to a water value of 2.40 grams. Hence the water value of the above system when charged, assuming the bomb to be of the capacity mentioned, is 380.12 grams.
If the cylinder holding the water be made of fiber or other non-conducting substance, its specific heat is best determined by filling it in a known temperature with water at a definite different temperature.
It is advisable to have the water cylinder of such a size as to permit the use of a quantity of water for the total immersion of the bomb which will weigh, with the water value of the apparatus, an even number of grams. In the case above, 2622.28 grams of water placed in the cylinder will make a water value of 3,000 grams, which is one quite convenient for calculation.
565. Computing the Calories of Combustion.—In the preceding paragraph has been given a brief account of the construction of the calorimeter and of the methods of standardizing it and securing the necessary corrections in the data directly obtained in its use. An illustration of the details of computing the calories of combustion taken from the paper of Stohmann, Kleber and Langbein, will be a sufficient guide for the analyst in conducting the combustion and in the use of the data obtained.[582]
Weight of substance burned, 1.07 grams.
Water value of system (water + apparatus), 2,500 grams.
Preliminary thermometric readings, t₁ = 26.8; t₂ = 27.2; t₃ = 27.7; t₄ = 28.1; t₅ = 28.5; tₙ₁ = 28.9.
Thermometric reading after combustion, Θ₁ = 28.9; Θ₂ = 202; Θ₃ = 213; Θ₄ = 214.2; Θₙ = 214.0.
Final thermometric readings, tʹ₁ = 214.0; tʹ₂ = 213.8; tʹ₃ = 213.6; tʹ₄ = 213.5; tʹ₅ = 213.3; tʹ₆ = 213.1; tʹ₇ = 212.9; tʹ₈ = 212.7; tʹ₉ = 212.6; tʹ₁₀ = 212.4; tʹₙ₂ = 212.2.
From the formulas given above the following numerical values are computed:
| n-1 | |||
| ∑ | Θr = Θ₁ + Θ₂ + Θ₃ + Θ₄ + | Θ₂ - Θ₁ | = 667. |
| 1 | 9 | ||
Substituting these values in the formula of Regnault-Pfaundler, the value of the correction for the influence of the external air is
| ∑ Δt = | [ | 0.42 - (-0.18) | ( | 677 + | 214 + 29 | - (5 × 27.9) | ) | - (4 × 0.42) | ] | = 0.45, |
| 213.1 - 27.9 | 2 |
which is to be added to the end temperature (Θₙ = 214.0).
The computation is then made from the following data:
| Corrected end temperature (Θₙ + 0.45) | 214.45 | = | 15°.3699 |
| Beginning temperature (Θ₁) | 28.90 | = | 12°.8406 |
| Increase in temperature | 185.55 | = | 2°.5293 |
| Total calories 2.5293 × 25000 | = | 6323.3 | |
| Of which there were due to iron burned | 9.1 | ||
| ” ” ” ” nitric acid dissolved | 8.2 | ||
| Total calories due to one gram of substance | 5893.5 | ||
The thermometric readings are given in the divisions of the thermometer which in this case are so adjusted as to have the number 28.90 correspond to 12°.8406, and each division is nearly equivalent to 0°.014 thermometric degree.
The number of calories above given is the proper one when the computation is made to refer to constant volume. By reason of the consumption of oxygen and the change of temperature, although mutually compensatory, the pressure may be changed at the end of the operation. The conversion of the data obtained at constant volume referred to constant pressure may be made by the following formula, in which [Q] represents the calories from constant volume and Q the desired data for constant pressure, O the number of oxygen atoms, H the number of hydrogen atoms in a molecule of the substance, and 0.291 a constant for a temperature of about 18°, at which the observations should be made. [Pg 576]
| Q = [Q] + | ( | H | - O | ) | 0.291. |
| 2 |
566. Calorimetric Equivalents.—By the term calorie is understood the quantity of heat required to raise one gram of water, at an initial temperature of about 18°, one degree. The term ‘Calorie’ denotes the quantity of heat, in like conditions, required to raise one kilogram of water one degree.
For purposes of comparison and for assisting the analyst in adjusting his apparatus so as to give reliable results, the following data, giving the calories of some common food materials, are given:
| Substance. Proteids. |
Calories. | Chemical composition. | ||||
|---|---|---|---|---|---|---|
| C. | H. | N. | S. | O. | ||
| Per cent. | Per cent. | Per cent. | Per cent. | Per cent. | ||
| Serum albumin | 5917.8 | 53.93 | 7.65 | 15.15 | 1.18 | 22.09 |
| Casein | 5867.0 | 54.02 | 7.33 | 15.52 | 0.75 | 22.38 |
| Egg albumin | 5735.0 | 52.95 | 7.50 | 15.19 | 1.51 | 22.85 |
| Meat free of fat and | 5720.0 | 52.11 | 6.76 | 18.14 | 0.96 | 22.66 |
| extracted with water | ||||||
| Peptone | 5298.8 | 50.10 | 6.45 | 16.42 | 1.24 | 25.79 |
| Proteids (mean) Glycerids. | 5730.8 | 52.71 | 7.09 | 16.02 | 1.03 | 23.15 |
| Butterfat | 9231.3 | |||||
| Linseed oil | 9488.0 | |||||
| Olive oil | 9467.0 | |||||
| Carbohydrates. | Formula. | |||||
| Arabinose | 3722.0 | C₅H₁₀O₅ | ||||
| Xylose | 3746.0 | C₅H₁₀O₅ | ||||
| Dextrose | 3742.6 | C₆H₁₂O₆ | ||||
| Levulose | 3755.0 | C₆H₁₂O₆ | ||||
| Sucrose | 3955.2 | C₁₂H₂₂O₁₁ | ||||
| Lactose | 3736.8 | C₁₂H₂₂O₁₁ + H₂O | ||||
| Maltose | 3949.3 | C₁₂H₂₂O₁₁ | ||||
567. Distinction between Butter and Oleomargarin.—Theoretically the heats of combustion of butter fat and oleomargarin are different and de Schweinitz and Emery propose to utilize this difference for analytical purposes.[583] The samples of pure butter fat examined by them afforded 9320, 9327 and 9362 calories, respectively. The calories obtained for various samples [Pg 577] of oleomargarin varied from 9574 to 9795. On mixing butter fat and oleomargarin, a progressive increase in calorimetric power is found, corresponding to the percentage of the latter constituent. Lards examined at the same time gave from 9503 to 9654 calories.
568. Preparation of Sample.—Fresh fruits and vegetables are most easily prepared for analysis by passing them through the pulping machine described on page 9. Preliminary to the pulping they should be separated into skins, cores, seeds and edible portions, and the respective weights of these bodies noted. Each part is separately reduced to a pulp and, at once, a small quantity of the well mixed substance placed in a flat bottom dish and dried, first at a low temperature, and finally at 100°, or somewhat higher, and the percentage of water contained in the sample determined. The bulk of the sample, three or four kilograms, is dried on a tray of tinned or aluminum wire, first at a low and then at a high temperature, until all or nearly all the moisture is driven off. The dried pulp is then ground to as fine a powder as possible and subjected to the ordinary processes of analysis; viz., the determination of the moisture, ash, nitrogen, fiber, fat and carbohydrates.
In this method of analysis it is customary to determine the carbohydrates, exclusive of fiber, by subtracting the sum of the per cents of the other constituents and the nitrogen multiplied by 6.25 from 100.
569. Separation of the Carbohydrates.—It is often desirable to determine the relative proportions of the more important carbohydrates which are found in fruits and vegetables. The pentoses and pentosans are estimated by the method described in paragraph 150. The cane sugar, dextrose and levulose are determined by extracting a portion of the substance with eighty per cent alcohol and estimating the reducing sugars in the extract before and after inversion by the processes described in paragraphs 238-251. The percentages of sugars deducted from the percentage of carbohydrates, exclusive of fiber, give the quantity of gums, pentosans, cellulose and pectose bodies present.
Pectose exists chiefly in unripe fruits. By the action of the fruit [Pg 578] acids and of a ferment, pectose, in the process of ripening, is changed into pectin and similar hydrolyzed bodies soluble in water. The gelatinous properties of boiled fruits and fruit juices are due to these bodies, boiling accelerating their formation. In very ripe fruits the pectin is completely transformed into pectic acids. The galactan is estimated as described in 585.
570. Examination of the Fresh Matter.—To avoid the changes which take place in drying fruits and vegetables, it is necessary to examine them in the fresh state. The samples may be first separated into meat and waste, as suggested above, or shredded as a whole. The moisture in the pulp is determined as indicated above, and in a separate portion the soluble matters are extracted by repeated treatment with cold water. The seeds, skins, cellulose, pectose and other insoluble bodies are thus separated from the sugars, pectins, pectic and other acids, and other soluble matters. The insoluble residue is rapidly dried and the relative proportions of soluble and insoluble matters determined. The estimation of these bodies is accomplished in the usual way.
571. Examination of Fruit and Vegetable Juices.—The fruits and vegetables are pulped, placed in a press and the juices extracted. The pressure should be as strong as possible and the press described in paragraph 280 is well suited to this purpose. The specific gravity of the expressed juice is obtained and the sucrose therein determined by polarization before and after inversion. The reducing sugars and the relative proportions of dextrose and levulose are determined in the usual manner. In grape juice dextrose is the predominant sugar while in many other fruits left hand or optically inactive sugars predominate. Soluble gums, dextrin, pectin etc., may be separated from the sugars by careful precipitation with alcohol, or the total solids, ash, nitrogen, ether extract and acids be determined and the carbohydrates estimated by difference. From the carbohydrates the total percentage of sugars is deducted and the remainder represents the quantity of pectin, gum and other carbohydrates present.
572. Separation of Pectin.—Pectin exists in considerable [Pg 579] quantities in the juice of ripe fruits (pears) and may be obtained in an approximately pure state from the juices by first removing proteids by the careful addition of tannin, throwing out the soluble lime salts with oxalic acid and precipitating the pectin with alcohol. On boiling with water, pectin is converted into parapectin, which gives a precipitate with lead acetate. Boiling with dilute acids converts pectin into metapectin, which is precipitated by a barium salt.
Pectic acid may be obtained by boiling an aqueous extract (carrots) with sodium carbonate and precipitating the pectic with hydrochloric acid. It is a jelly-like body and dries to a horny mass.
573. Determination of Free Acid.—The free acid, or rather total acidity of fruits, is determined by the titration of their aqueous extracts or expressed juices with a set alkali. In common fruits and vegetables the acidity is calculated to malic C₄H₆O₅, in grapes to tartaric C₄H₆O₆, and in citrous fruits to citric acid C₆H₈O₇. Many other acids are found in fruits and vegetables, but those mentioned are predominant in the classes given.
574. Composition of Common Fruits.—The composition of common fruits in this country has been extensively investigated at the California Station and the following data are derived chiefly from its bulletins.[584]
| Name. | Total weight. |
Rind skin. |
Seed. | Pulp. | Juice. | (A) | (B) |
|---|---|---|---|---|---|---|---|
| grams. | per cent. | per cent. | per cent. | cubic centimeters. |
Per cent. | Per cent. | |
| Naval orange | 300 | 28.4 | 27.7 | 107 | 9.92 | 4.80 | |
| Mediterranean sweet orange | 202 | 27.0 | 0.8 | 24.0 | 86 | 9.70 | 4.35 |
| St. Michael’s orange | 138 | 19.2 | 1.6 | 25.9 | 65.4 | 8.71 | 3.48 |
| Malta Blood orange | 177 | 31.0 | 24.0 | 71.0 | 10.30 | 5.85 | |
| Eureka lemon | 104 | 32 | 0.12 | 24.5 | 38 | 2.08 | 0.57 |
| Flesh | Per cent | ||||||
| Apricot | 62.4 | 93.85 | 6.15 | 10.0 | 90.0 | 13.31 | |
| Prune | 25.6 | 94.2 | 5.8 | 21.2 | 78.8 | 20.0 | |
| Plum | 60.4 | 95.2 | 4.8 | 24.7 | 75.3 | 17.97 | |
| Peach | 185 | 93.8 | 6.2 | 22.5 | 77.5 | 17.0 | |
| Skin | Cores | ||||||
| Apple | 183 | 17.0 | 7.0 | 10.26‡ | 1.53‡ | ||
| ‡ In whole fresh fruit. | |||||||
| Name. | Acid | In whole fruit. | |||
|---|---|---|---|---|---|
| Nitrogenous bodies. |
Water. | (C) | Ash. | ||
| per cent. | per cent. | per cent. | per cent. | per cent. | |
| Naval orange | 1.02 | 1.31 | 86.56 | 13.04 | 0.40 |
| Mediterranean sweet orange | 1.38 | 0.96 | 85.83 | 13.06 | 0.41 |
| St. Michael’s orange | 1.35 | 1.43 | 84.10 | 15.42 | 0.48 |
| Malta Blood orange | 1.61 | 1.05 | 84.50 | 15.05 | 0.45 |
| Eureka lemon | 7.66 | 0.94 | 85.99 | 13.50 | 0.51 |
| Apricot | 0.68 | 1.25 | 85.16 | 14.35 | 0.49 |
| Prune | 0.40 | 1.01 | 77.38 | 22.18 | 0.44 |
| Plum | 0.48 | 1.33 | 77.43 | 22.04 | 0.53 |
| Peach | 0.25 | 82.50 | 16.95 | 0.55 | |
| Apple[585] | 0.11 | 86.43 | 13.28 | 0.29 | |
[Pg 580] 575. Composition of Ash of Fruits.—Two or three kilograms of the dried sample are incinerated at a low temperature and burned to a white ash in accordance with the directions given in paragraphs 28-32.
The composition of the ash is determined by the methods already described.[586]
The pure ash of some common whole fruits has the following composition:[587]
| Name. | (A) | Per cent potash. |
Per cent soda. |
Per cent lime. |
Per cent magnesia. |
Per cent ferric oxid. |
(B) |
|---|---|---|---|---|---|---|---|
| Prune | 0.47 | 63.83 | 2.65 | 4.66 | 5.47 | 2.72 | 0.39 |
| Apricot | 0.51 | 59.36 | 10.26 | 3.17 | 3.68 | 1.68 | 0.37 |
| Orange | 0.43 | 48.94 | 2.50 | 22.71 | 5.34 | 0.97 | 0.37 |
| Lemon | 0.53 | 48.26 | 1.76 | 29.87 | 4.40 | 0.43 | 0.28 |
| Apple | 1.44 | 35.68 | 26.09 | 4.08 | 8.75 | 1.40 | |
| Pear | 1.97 | 54.69 | 8.52 | 7.98 | 5.22 | 1.04 | |
| Peach | 4.90 | 27.95 | 0.23 | 8.81 | 17.66 | 0.55 | |
| Name. | (C) | (D) | Per cent silica. |
Per cent chlorin. |
|||
| Prune | 14.08 | 2.68 | 3.07 | 0.34 | |||
| Apricot | 13.09 | 2.63 | 5.23 | 0.45 | |||
| Orange | 12.37 | 5.25 | 0.65 | 0.92 | |||
| Lemon | 11.09 | 2.84 | 0.66 | 0.39 | |||
| Apple | 13.59 | 6.09 | 4.32 | ||||
| Pear | 15.20 | 5.69 | 1.49 | ||||
| Peach | 43.63 | 0.37 | |||||
576. Dried Fruits.—A method of preserving fruits largely practiced consists in subjecting them, in thin slices or whole, to the action of hot air until the greater part of the moisture is driven off. The technique of the process is fully described in recent publications.[588] It has been shown by Richards that fruit subjected to rapid evaporation undergoes but little change aside from the loss of water.[589]
In the analyses of dried fruits the methods already described are used. The presence of pectin renders the filtration of the aqueous extract somewhat difficult, and in many cases it is advisable to determine the sugars present in the extract without previous filtration.
577. Zinc in Evaporated Fruits.—Fruits are commonly evaporated on trays made of galvanized iron. In these instances a portion of the zinc is dissolved by the fruit acids, and will be found as zinc malate etc., in the finished product. The presence of zinc salts is objectionable for hygienic reasons, and therefore the employment of [Pg 581] galvanized trays should be discontinued. The presence of zinc in evaporated fruits may be detected by the following process.[590] The sample is placed in a large platinum dish and heated slowly until dry and in incipient combustion. The flame is removed and the combustion allowed to proceed, the lamp being applied from time to time in case the burning ceases. When the mass is burned out it will be found to consist of ash and char, which are ground to a fine powder and extracted with hydrochloric or nitric acid. The residual char is burned to a white ash at a low temperature, the ash extracted with acid, the soluble portion added to the first extract and the whole filtered. The iron in the filtrate is oxidized by boiling with bromin water and the boiling continued until the excess of bromin is removed. A drop of methyl orange is placed in the liquid and ammonia added until it is only faintly acid. The iron is precipitated by adding fifty cubic centimeters of a solution containing 250 grams of ammonium acetate in a liter and raising the temperature to about 80°. The precipitate is separated by filtration and washed with water at 80° until free of chlorids. The filtrate is saturated with hydrogen sulfid, allowed to stand until the zinc sulfid settles and poured on a close filter. It is often necessary to return the filtrate several times before it becomes limpid. The collected precipitate is washed with a saturated solution of hydrogen sulfid containing a little acetic acid. The precipitate and filter are transferred to a crucible, dried, ignited and the zinc weighed as oxid. Small quantities of zinc salts added to fresh apples which were dried and treated as above described, were recovered by this method without loss. Other methods of estimating zinc in dried fruits are given in the bulletin cited.
Evaporated apples contain a mean content of 23.85 per cent of water and 0.931 per cent of ash.
The mean quantity of zinc oxid found in samples of apples dried in the United States is ten milligrams for each 100 grams of the fruit, an amount entirely too small to produce any toxic effects. When zinc exists in the soil it will be found as a natural constituent in the crop.[591]
578. Composition of Watermelons and Muskmelons.—In the examination of melons a separation of the rind, seeds and meat is [Pg 582] somewhat difficult of accomplishment, since the line of demarcation is not distinct. In watermelons the separation of rind and meat is made at the point where the red color of the meat disappears. In muskmelons no such definite point is found and in the examination of these they are taken as a whole. The total moisture, ash and nitrogen may be determined in the whole mass or in the separate portions. The sugars are most conveniently determined in the expressed juices. The mean composition of the melons given below is that obtained from analyses made in the Department of Agriculture.[592]
| Composition of Melons. | ||||
|---|---|---|---|---|
| Total weight, grams. |
Juice, per cent. |
Total proteids, per cent. |
Ash, per cent. |
|
| Watermelons | 10330 | meat 83.99 | 6.12 | 0.37 |
| rind 81.02 | ||||
| Muskmelons | 3407 | 80.23 | 6.45 | 0.57 |
| Composition of Juice. |
||||
| Sucrose in juice, per cent. |
Reducing sugars in juice, per cent. |
Ash per cent. |
||
| Watermelons | meat 1.92 | meat 4.33 | meat 0.31 | |
| rind 0.34 | rind 2.47 | rind 0.38 | ||
| Muskmelons | 1.02 | 3.04 | 0.53 | |
579. Special Analysis.—Aside from the examination of teas and coffees for adulterants, the only special determinations which are required in analyses are the estimation of the alkaloid (caffein) and of the tannin contained therein. It is chiefly to the alkaloid that the stimulating effects of the beverages made from tea and coffee are due. The determination of the quantity of tannin contained in tea and coffee is accomplished by the processes described under the chapter devoted to that glucosid.
The general analysis, viz., the estimation of water, ether extract, total nitrogen, fiber, carbohydrates and ash, with the exceptions noted above, is conducted by the methods which have already been given.
For detailed instructions concerning the detection of adulterants of tea and coffee the bulletins of the Chemical Division, Department of Agriculture, may be consulted.[593]
[Pg 583] 580. Estimation of Caffein (Thein).—The method adopted by Spencer, after a thorough trial of all the usual processes for estimating this alkaloid, is as follows:[594] To three grams of the finely powdered tea or coffee, in a 300 cubic centimeter flask, add about a quarter of a liter of water, slowly heat to the boiling point, using a fragment of tallow to prevent frothing, and boil gently for half an hour. When boiling begins, the flask should be nearly filled with hot water and more added from time to time to compensate for the loss due to evaporation. After cooling, add a strong solution of basic lead acetate until no further precipitation is produced, complete the volume to the mark with water, mix and throw on a filter. Precipitate the lead from the filtrate by hydrogen sulfid and filter. Boil a measured volume of this filtrate to expel the excess of hydrogen sulfid, cool and add sufficient water to compensate for the evaporation. Transfer fifty cubic centimeters of this solution to a separatory funnel and shake seven times with chloroform. Collect the chloroform solution in a tared flask and remove the solvent by gentle distillation. A safety bulb, such as is used in the kjeldahl nitrogen method, should be employed to prevent entrainment of caffein with the chloroform vapors.
The extraction with chloroform is nearly complete after shaking out four times; a delicate test, however, will usually reveal the presence of caffein in the watery residue even after five or six extractions, hence seven extractions are recommended for precautionary reasons. The residual caffein is dried at 75° for two hours and weighed.
The principal objection which has been made to Spencer’s method is that the boiling with water is not continued for a sufficient length of time. For the water extraction, Allen prescribes at least six hours cohobation.[595] In this method six grams of the powdered substance are boiled with half a liter of water for six hours in a flask, with a condenser, the decoction filtered, the volume of the filtrate completed to 600 cubic centimeters with the wash water, heated to boiling, and four cubic centimeters of strong lead acetate solution added, the mixture boiled for ten minutes, filtered and half a liter of the filtrate evaporated [Pg 584] to fifty cubic centimeters. The excess of lead is removed with sodium phosphate and the filtrate and washings concentrated to about forty cubic centimeters. The caffein is removed by shaking four times with chloroform. Older but less desirable processes are fully described by Allen.[596]
In France this method is known as the process of Petit and Legrip, and it has been worked out in great detail by Grandval and Lajoux and by Petit and Terbat.[597]
581. Estimation of Caffein by Precipitation with Iodin.—The caffein in this method is extracted, the extract clarified by lead acetate and the excess of lead removed as in Spencer’s process described above. The caffein is determined in the acidified aqueous solution thus prepared, according to the plan proposed by Gomberg, as follows:[598]
Definite volumes of the aqueous solution of the caffein are acidulated with sulfuric and the alkaloid precipitated by an excess of a set solution of iodin in potassium iodid. After filtering, the excess of iodin in an aliquot part of the filtrate is determined by titration with a tenth normal solution of sodium thiosulfate. The filtration of the iodin liquor is accomplished on glass wool or asbestos. The results of the analyses are calculated from the composition of the precipitated caffein periodid; viz., C₈H₁₀N₄O₂.HI.I₄. The weight of the alkaloid is calculated from the amount of iodin required for the precipitation by the equation 4I: C₈H₁₀N₄O₂ = 508: 194. From this equation it is shown that one part of iodin is equivalent to 0.3819 part of caffein, or one cubic centimeter of tenth normal iodin solution is equal to 0.00485 gram of iodin.
In practice, it is recommended to divide the aqueous extract of the alkaloid, prepared as directed above, into two portions, one of which is treated with the iodin reagent without further preparation, and the other after acidulation with sulfuric. After ten minutes, the residual iodin is estimated in each of the solutions as indicated above. The one portion, containing only the acetic acid resulting from the decomposition of the lead acetate, serves to indicate whether the aqueous solution of the caffein contains other bodies than that alkaloid capable of forming a precipitate with the reagent, since the caffein itself is not precipitated even in presence of strong acetic acid. [Pg 585]
In the solution acidulated with sulfuric, the caffein, together with the other bodies capable of combining with iodin, is precipitated. The residual iodin is determined in each case, and thus the quantity which is united with the caffein is easily ascertained. The weight of iodin which has entered into the precipitated caffein periodid multiplied by 0.3819 gives the weight of the caffein in the solution.
Gomberg’s method has been subjected to a careful comparative study by Spencer and has been much improved by him in important particulars.[599]
It is especially necessary to secure the complete expulsion of the hydrogen sulfid and to observe certain precautions in the addition of the iodin reagent. The precipitation should be made in a glass-stoppered flask, shaking thoroughly after the addition of the iodin and collecting the precipitate on a gooch. As thus modified, the iodin process gives results comparable with those obtained by Spencer’s method, and it can also be used to advantage in estimating caffein in headache tablets in the presence of acetanilid.
582. Freeing Caffein of Chlorophyll.—Any chlorophyll which may pass into solution and be found in the caffein may be removed by dissolving the caffein in ten per cent sulfuric acid, filtering, neutralizing with ammonia and evaporating to dryness. The residue is taken up with chloroform, the chloroform removed at a low temperature and the pure caffein thus obtained.[600]
583. Proteid Nitrogen.—The proteid nitrogen in tea and coffee may be determined in the residue after extraction of the alkaloid by boiling water as described above. More easily it is secured by determining the total nitrogen in the sample and deducting therefrom the nitrogen present as caffein. The remainder, multiplied by 6.25, will give the quantity of proteid matter.
584. Carbohydrates of the Coffee Bean.—The carbohydrates of the coffee bean include those common to vegetable substances; viz., cellulose, pentosan bodies (xylan, araban), fiber etc., together with certain sugars, of which sucrose is pointed out by Ewell as the chief.[601] In smaller quantities are found a galactose yielding body (galactan), as pointed out by Maxwell, a dextrinoid and a trace of a sugar reducing [Pg 586] alkaline copper solution.
The sucrose may be separated from the coffee bean by the following process:[602] The finely ground flour is extracted with seventy per cent alcohol, the extract clarified with lead acetate, filtered, the lead removed from the filtrate with hydrogen sulfid, the excess of the gas removed by boiling, the filtrate evaporated in a partial vacuum to a sirup and the sucrose crystallized from a solution of the sirup in alcohol.
For a quantitive determination, ten grams of the coffee flour are extracted with ether and the residue with seventy-five per cent alcohol. This process, conducted in a continuous extraction apparatus, should be continued for at least twenty-four hours. The alcohol is removed by evaporation, the residue dissolved in water, clarified with basic lead acetate, filtered, the precipitate washed, the lead removed, again filtered, the filtrate washed and wash water and filtrate made to a definite volume. In an aliquot part of this solution the sugars are determined by the alkaline copper method, both before and after inversion. From the data obtained the percentage of sucrose is calculated.
In a coffee examined by Ewell the percentage of sucrose was found to be 6.34. The pentose yielding constituents of the coffee bean amount to from eight to ten per cent.
When coffee meal is extracted with a five per cent solution of sodium carbonate, a gummy substance is obtained, which is precipitable by alcohol. This gum, after washing with hydrochloric acid containing alcohol, gives a gray, translucent, hard mass on drying. On hydrolysis it yielded 75.2 per cent of dextrose, on distillation with hydrochloric acid, thirteen per cent of furfuraldehyd and, on oxidation with nitric acid, 18.7 per cent of mucic acid. This gum, therefore, consists chiefly of a mixture of galactan, xylan and araban.
585. Estimation of Galactan.—From three to five grams of the substance supposed to contain galactan are placed in a beaker with sixty cubic centimeters of nitric acid of 1.15 specific gravity. The mixture is evaporated on a steam bath until it is reduced to one-third [Pg 587] of its original volume, allowed to stand for twenty-four hours, ten cubic centimeters of water added, well stirred and again allowed to stand for twenty-four hours, until the mucic acid is separated in a crystalline form. To remove impurities from the mucic acid it is separated by filtration, washed with not to exceed twenty cubic centimeters of water, placed together with the filter in the beaker, from twenty-five to thirty cubic centimeters of ammonium carbonate solution, containing one part of dry ammonium carbonate, nineteen parts of water and one part of ammonium hydroxid, added and heated to near the boiling point. The mucic acid is dissolved by the ammonium carbonate solution and any insoluble impurity separated by filtration, the filtrate being received in a platinum dish, the residue well washed and the entire filtrate and wash water evaporated to dryness on a steam bath acidified with dilute nitric, well stirred and allowed to stand until the mucic acid separates in a crystalline form. The separation is usually accomplished in half an hour, after which time the crystals of mucic acid are collected on a tared filter, or gooch, and washed with not to exceed fifteen cubic centimeters of water followed with sixty cubic centimeters of alcohol, then with ether, dried at 100° and weighed. For computing the amount of galactose, one gram of the mucic acid is equal to 1.333 of galactose and one gram of galactose is equal to nine-tenths gram of galactan. Before the commencement of the operation, the material should be freed of fatty matters in the case of oily seeds and other substances similar thereto.[603]
586. Revised Factors for Pentosans.—The factors given in paragraph 154 have lately been recalculated by Mann, Kruger and Tollens, and as a result of their investigations the following factors are now recommended.[604] The quantity of furfurol is derived from the weight of furfurolhydrazone obtained by the formula:
The pentoses (xylose, arabinose) may be calculated from the pentosans (xylan, araban) by dividing by 0.88. [Pg 588]
The method of procedure preferred for the estimation of the pentosans is that described in paragraph 157. The phloroglucin is dissolved in hydrochloric acid of 1.06 specific gravity before it is added to the furfurol distillate. The latest factor for converting the phloroglucid obtained into furfurol is to divide by 1.82 for small quantities and 1.93 for large quantities. After the furfurol is obtained, the factors given above are applied.
587. Application of Roentgen Rays to Analysis.—The detection of mineral matters in vegetable substances by roentgen photography has been proposed by Ranvez.[605] This process will prove extremely valuable in detecting the lacing of teas with mineral substances. Practically, it has been applied by Ranvez in the detection of mineral substances mixed with saffron with fraudulent intent.
Barium sulfate is often mixed with saffron for the purpose of increasing its weight. Pure saffron and adulterated samples are enclosed in capsules of black paper and exposed on the same sensitive plate for a definite time to the rays emanating from a crookes tube. In this case the pure saffron forms only a very faint shadow in the developed negative, while the parts to which barium sulfate are attached produce strong shadows. The principle involved is applicable to a wide range of analytical research.
588. Occurrence and Composition.—The tannins and allied bodies, which are of importance in this connection, are those which occur in food products and beverages and also those made use of in the leather industry. The term tannin is applied to a large class of astringent substances, many of which are glucosids. Tannic acid is the chief constituent of the tannins, and is found in a state of comparative purity in nutgalls. The source from which the tannic acid is derived is indicated by a prefix to the name, e. g., gallotannic, from nutgalls, and caffetannic, from coffee etc. The tannins have lately been the theme of a critical study by Trimble, and the reader is referred to his work for an exhaustive study of the subject.[606] Tannin is one of the most widely diffused compounds, occurring in hundreds [Pg 589] of plants. Commercially, the oaks and hemlocks are the most important plants containing tannin. The sumach, mangrove, canaigre, palmetto and many others have also been utilized as commercial sources of tannin. The tannins as a class are amorphous and odorless. They are slightly acid and strongly astringent. Their colors vary from dark brown to pure white. They are soluble in water, alcohol, ether and glycerol and insoluble in chloroform, benzol, petroleum ether, carbon bisulfid and the oils. The tannins give blue or green precipitates with iron salts and most of them brown precipitates with potassium bichromate. They are all precipitated by gelatin or albumin. Tannins are not only generally of a glucosidal nature, but are found quite constantly associated with reducing sugars, or in unstable combination therewith.
The reducing sugars may be separated from the tannin by precipitating the latter with lead acetate and determining the glucose in the filtrate after the removal of the lead. A separate portion of the tannin is hydrolyzed with sulfuric or hydrochloric acid and the reducing sugars again determined. Any excess of sugars over the first determination is due to the hydrolysis of the tannin glucosid.
589. Detection and Estimation of Tannins.—The qualitive reactions above mentioned serve to detect the presence of a tannin. Of the iron salts ferric acetate or chlorid is preferred. Ferrous salts do not give any reaction with dilute tannin solutions. An ammoniacal solution of potassium ferricyanid forms with tannins a deep red color changing to brown. In quantitive work the tannins are mostly determined by precipitation with metallic salts, by treatment with gelatin or hide powder, or by oxidation with potassium permanganate. Directions for the estimation of glucosids in general are found in Dragendorff’s book.[607]
590. Precipitation with Metallic Salts.—The methods depending on precipitation of the tannins with metallic salts are but little used and only one of them will be mentioned here. A full description of the others is contained in Trimble’s book.[608] A method for the determination of caffetannic acid in coffee has been [Pg 590] worked out by Krug and used with some satisfaction.[609]
In this method two grams of the coffee meal are digested for thirty-six hours with ten cubic centimeters of water, a little more than twice that volume of ninety-five per cent alcohol added and the digestion continued for a day. The contents of the flask are poured on a filter and the residue washed with alcohol. The filtrate contains tannin, caffetannic acid and traces of coloring matter and fat. It is heated to the boiling point and clarified with a solution of lead acetate. A caffetannate of lead containing forty-nine per cent of the metal is precipitated. As soon as the precipitate has become flocculent it is collected on a filter, washed with ninety per cent alcohol until the soluble lead salts are all removed, then with ether and dried. The composition of the precipitate is represented by the formula Pb₃(C₁₅H₁₅O₈)₂. The caffetannic acid is calculated by the equation: Weight of precipitate: weight of caffetannic acid = 1267: 652.
591. The Gelatin Method.—The precipitation of tannin with gelatin is the basis of a process for its quantitive estimation which, according to Trimble, is conducted as follows:[610] Two and a half grams of gelatin and ten grams of alum are dissolved in water and the volume of the solution made up to one liter. The solution of gelatin and also that of the tannin are heated to 70° and the tannin is precipitated by adding the gelatin reagent slowly, with constant stirring, until the precipitate coagulates, and, on settling, leaves a clear liquor in which no further precipitate is produced on adding a few drops more of the reagent. In case the clearing of the mixture do not take place readily, the process should be repeated with a more dilute tannin solution. The precipitate is collected on two counterpoised filter papers one placed inside the other, dried at 110° and weighed, the empty filter paper being placed on the pan with the weights. For pure tannin (gallotannic acid) fifty-four per cent of the weight of the precipitate are tannin. Ammonium chlorid and common salt have been used in place of the alum in preparing the reagent, but if the proportion of alum mentioned above be used, satisfactory results will be obtained in most cases. [Pg 591]
592. The Hide Powder Method.—The principle of this method is based on the change in specific gravity, i. e., total solids, which a tannin solution will undergo when brought into contact with raw hides in a state of fine subdivision. The hide powder absorbs the tannin, and the total solid content of the solution is correspondingly diminished. The method is conducted according to the official directions as follows:[611]
Preparation of the Sample.—The bark, wood, leaves or other materials holding the tannins, are dried and ground to a fine powder and thoroughly extracted with water as mentioned below. In each case the solution or extraction is made as thorough as possible and the volume of the extract is made up to a definite amount.
Quantity of Tanning Material.—Use such an amount of the tanning material as shall give in 100 cubic centimeters of the filtered solution about one gram of dry solids. In the case of barks, woods, leaves and similar materials, transfer to a half liter flask, fill the flask with water at approximately 80° and let stand over night in a bath which is kept at 80°, cool, fill to the mark, shake well and filter. In the case of extracts and sweet liquors, wash the proper quantity into a half liter flask with water at approximately 80°, almost filling the flask, cool and fill to the mark.
Determination of Moisture.—Dry five grams of the sample in a flat bottom dish at the temperature of boiling water until the weight becomes constant.
Determination of Total Solids.—Shake the solution, which should be at a temperature of about 20°, and immediately remove 100 cubic centimeters with a pipette, evaporate in a weighed dish and dry to constant weight at the temperature of boiling water.
Determination of Soluble Solids.—Filter a portion of the solution through a folded filter, returning the filtrate to the filter twice and adding a teaspoonful of kaolin, if necessary. Evaporate 100 cubic centimeters of the filtrate and dry as above.
Determination of Tanning Substances.—Extract twenty grams of hide powder by shaking for five minutes with 250 cubic centimeters of water, filter through well washed muslin or linen, repeat the operation three times and dry as much as possible in a suitable press. Weigh the [Pg 592] wet powder and determine the residual moisture in about one-fourth of the whole by drying to constant weight at 100°. Shake 200 cubic centimeters of the unfiltered solution of the tannin with the rest of the moist hide powder for about five minutes, add five grams of barium sulfate, shake for one minute and filter through a schleicher and schüll folded filter, No. 590, fifteen centimeters in diameter, returning the first twenty-five cubic centimeters of the filtrate. Evaporate 100 cubic centimeters of the clear filtrate and dry the residue to constant weight at a temperature of boiling water. The difference between the soluble solids obtained in the filtered tannin solution and the residue as obtained above is the amount of tanning material absorbed by the hide powder. This weight must be corrected for the water retained by the hide powder. The shaking must be conducted by means of a mechanical shaker, in order to remove all the tannin substance from the solution. The simple machine used by druggists, and known as the milkshake, is recommended.
Testing the Hide Powder.—Shake ten grams of the hide powder with 200 cubic centimeters of water for five minutes, filter through muslin or linen, squeeze out thoroughly by hand, replace the residue in the flask and repeat the operation twice with the same quantity of water. Pass the last filtrate through paper until a perfectly clear liquid is obtained. Evaporate 100 cubic centimeters of the final filtrate in a weighed dish, dry at 100° until the weight is constant. If the residue amount to more than ten milligrams the sample should be rejected. The hide powder must be kept in a dry place and tested once a month.
Prepare a solution of pure gallotannic acid by dissolving five grams in one liter of water. Determine the total solids by evaporating 100 cubic centimeters of this solution and drying to constant weight. Treat 200 cubic centimeters of the solution with hide powder exactly as described above. The hide powder must absorb at least ninety-five per cent of the total solids present. The gallotannic acid used must be completely soluble in water, alcohol, acetone and acetic ether and should contain not more than one per cent of substances not removed by digesting with excess of yellow mercuric oxid on the steam bath for two hours. [Pg 593]
Testing the Non-Tannin Filtrate. For Tannin:—Test a small portion of the clear non-tannin filtrate with a few drops of a ten per cent solution of gelatin. A cloudiness indicates the presence of tannin, in which case the determination must be repeated, using twenty-five grams of hide powder instead of twenty grams.
For Soluble Hide:—To a small portion of the clear non-tannin filtrate, add a few drops of the original solution, previously filtered to remove reds. A cloudiness indicates the presence of soluble hide due to incomplete washing of the hide powder. In this case, repeat the determination with perfectly washed hide powder.
593. The Permanganate Gelatin Method.—This process, which is essentially the method of Löwenthal, as improved by Councler, Schroeder and Proctor and as used by Spencer for the determination of tannin in teas, is conducted as described below.[612] The principle of the process is based on the oxidation of all bodies in solution oxidizable by potassium permanganate, the subsequent precipitation of the tannin by a gelatin solution, and the final oxidation, by means of permanganate, of the remaining organic bodies. The difference between the total oxidizable matter and that left after the precipitation of the tannin represents the tannin originally in solution.
Reagents Required.—The following reagents are necessary to the proper conduct of the potassium permanganate process:
(1). Potassium permanganate solution containing about one and a third grams of the salt in a liter:
The potassium permanganate solution is set by titration against the decinormal oxalic acid solution mentioned below. The end reaction with the indicator must be of the same tint in all the titrations, i. e., either golden yellow or pink.
(2). Tenth-normal oxalic acid solution for determining the exact titer of the permanganate solution:
(3). Indigo-carmin solution to be used as an indicator and containing six grams of indigo-carmin and fifty cubic centimeters of sulfuric acid in a liter. The indigo-carmin must be very pure and quite free of indigo-blue. [Pg 594]
(4). Gelatin solution, prepared by digesting twenty-five grams of gelatin at room temperature for one hour in a saturated solution of sodium chlorid, then heating until solution is complete, cooling and making the volume up to one liter:
(5). A salt acid solution, made by adding to 975 cubic centimeters of a saturated solution of sodium chlorid, enough strong sulfuric acid to bring the volume of the mixture to one liter:
(6). Powdered kaolin for promoting filtration.
The Process.—Five grams of the finely powdered tea (or other vegetable substance containing tannin) are boiled with distilled water in a flask of half a liter capacity for half an hour. The distilled water should be at room temperature when poured over the powdered tea. After cooling, the volume of the decoction is completed to half a liter, and the contents of the flask poured on a filter. To ten cubic centimeters of the filtered tea infusion are added two and a half times as much of the indigo-carmin solution and about three-quarters of a liter of distilled water.
The permanganate solution is run in from a burette, a little at a time, with vigorous stirring, until the color changes to a light green, and then drop by drop until the final color selected for the end of the reaction, golden yellow or faint pink, is obtained. The number of cubic centimeters of permanganate required is noted and represented by a in the formula below. The titration should be made in triplicate and the mean of the two more nearly agreeing readings taken as the correct one.
One hundred cubic centimeters of the filtered tea infusion, obtained as directed above, are mixed with half that quantity of the gelatin reagent, the first named quantity of the acid salt solution added, together with ten grams of the powdered kaolin, the mixture well shaken for several minutes and poured on a filter. Twenty-five cubic centimeters of the filtrate, corresponding to ten of the original tea solution are titrated with the permanganate reagent, under the conditions given above, and the reading of the burette made and represented by b. The quantity of permanganate solution, viz., c, required to oxidize the tannin is calculated from the formula a - b = c. The relation between the permanganate, oxalic acid and tannin is such that 0.04157 gram of gallotannic acid is equivalent to 0.063 gram of oxalic acid. The [Pg 595] relation between the oxalic acid solution and the permanganate having been previously determined the data for calculating the quantity of tannin, estimated as gallotannic acid, are at hand.
594. The Permanganate Hide Powder Method.—Instead of throwing out the tannin with gelatin it may be absorbed by hide powder. The principle of the process, save this modification, is the same as in the method just described. As described by Trimble, the analysis is conducted according to the following directions:[613]
Reagents Required.—The reagents required for conducting the permanganate hide powder process are as follows:
1. Permanganate Solution.—Ten grams of pure potassium permanganate are dissolved in six liters of water. The solution is standardized with pure tannin. The moisture in the pure tannin is determined by drying at 100° to constant weight and then a quantity of the undried substance, representing two grams of the dried material, is dissolved in one liter of water. Ten cubic centimeters of this solution and double that quantity of the indigo solution to be described below, are mixed with three-quarters of a liter of water and the permanganate solution added from a burette with constant stirring until the liquid assumes a greenish color and then, drop by drop, until a pure yellow color with a pinkish rim is obtained. Fifty cubic centimeters of the pure tannin solution are digested, with frequent shaking, with three grams of hide powder which has been previously well moistened and dried in a press for eighteen or twenty hours, the contents of the flask thrown on a filter and ten cubic centimeters of the filtrate titrated with the permanganate solution as directed above. The difference between the amount of permanganate solution required for the first and second titrations represents the amount of pure tannin or oxidizable matter removed by the hide powder.
2. Indigo Solution.—The indicator which is used in the titrations is prepared by dissolving thirty grams of sodium sulfindigotate in three liters of dilute sulfuric acid made by adding one volume of the strong acid to three volumes of water. The solution is shaken for a few minutes, thrown upon a filter and the insoluble [Pg 596] residue washed with sufficient water to make the volume of the filtrate six liters.
3. Hide Powder.—The hide powder used should be white, wooly in character and sufficiently well extracted with water to afford no other extract capable of oxidizing the permanganate solution.
The Process.—The reagents having been prepared and tested as above, the solution of the substance containing the tannin, prepared as described further on, is titrated first with the permanganate solution in the manner already given. Fifty cubic centimeters of the tannin solution are then shaken, from, time to time for eighteen hours, with three grams of hide powder, thrown upon a filter and ten cubic centimeters of the filtrate titrated with the potassium permanganate as above described. From the data obtained, the quantity of permanganate solution corresponding to the tannin removed by the hide powder is easily calculated. The value of the permanganate solution having been previously set with a pure tannin, renders easy of calculation the corresponding amount of pure tannin in the solution under examination.
595. Preparation of the Tannin Infusion.—A sample weighing about a kilogram should be secured, representing as nearly as possible the whole of the materials containing tannin in a given lot. The sample is reduced to a fine powder and passed through a sieve containing apertures about a millimeter in diameter. The quantity of the sample used for the extraction depends largely upon its content of tannin. Five grams of nutgalls, ten grams of sumach or twenty grams of oak bark represent about the quantities necessary for these classes of tannin-holding materials. The sample is boiled for half an hour with half a liter of water, filtered through a linen bag into a liter flask and washed and pressed with enough water to make the volume of the filtrate equal to one liter. The proper quantities of this solution are used for the analytical processes described above.
596. Fermented and Unfermented Tobacco.—Samples of tobacco may [Pg 597] reach the analyst either in the fermented or unfermented state. As a basis for comparison, it is advisable in all cases to determine the constituents of the sample before fermentation sets in. The analysis, after fermentation is complete, will then show the changes of a chemical nature which it has undergone during the process of curing and sweating. Only tobacco which has undergone fermentation is found to be in a suitable condition for consumption. In addition to the natural constituents of tobacco, it may contain, in the manufactured state, flavoring ingredients such as licorice and sugar, coloring matters and in some instances, it is said, opium or other stimulating drugs. It is believed, however, that opium is not often found in manufactured tobacco, and it has never been found in this laboratory in cigarettes, although all the standard brands have been examined for it.[614]
In researches made at the Connecticut Station it is shown that fermentation produces but little change in the relative quantities of nitric acid, ammonia, fiber and starch in the leaves, while those of nicotin, albuminoids and amids are diminished. This is not in harmony with the generally accepted theory that starch is inverted and fermented during the process.[615]
The nature of the ferments which are active in producing the changes which tobacco undergoes in curing, is not definitely understood. Some of the organic constituents of the tobacco undergo a considerable change during the process. Any sugar which is found in the freshly cured leaves disappears wholly or in part. As products of fermentation may also be found succinic, fumaric, formic, acetic, propionic and butyric acids.
597. Acid and Basic Constituents of Tobacco.—In unfermented and fermented tobacco are found certain organic acids, among the most important of which are citric, malic, oxalic, pectic and tannic. Of the inorganic acids the chief which are found are nitric, sulfuric and hydrochloric. Among the bases ammonia and nicotin are the most important. Ammonia is found in the unfermented tobacco in only small quantities, but in the fermented product it may sometimes reach as high as half a per cent. The presence of these two nitrogenous bases in [Pg 598] tobacco renders the estimation of the proteid matter contained therein somewhat tedious and difficult.
598. Composition of Tobacco Ash.—The mineral constituents of tobacco are highly important from a commercial point of view. The burning properties of tobacco depend largely upon the nature of its mineral constituents. A sample containing a large quantity of chlorids burns much less freely than one in which the sulfates and nitrates predominate. For this reason, the use of potash fertilizers containing large amounts of chlorin is injudicious in tobacco culture, the carbonates and sulfates of potash being preferred. The leaves of the tobacco plant contain a much larger percentage of mineral constituents than the stems, their respective contents of pure ash, that is ash free from carbon dioxid, carbon and sand, being about seventeen and seven. The pure ash of the leaves has the following mean composition: Potash 29.1 per cent, soda 3.2 per cent, lime 36.0 per cent, magnesia 7.4 per cent, iron oxid 2.0 per cent, phosphoric acid 4.7 per cent, sulfuric acid 6.0 per cent, silica 5.8 per cent, and chlorin 6.7 per cent.[616]
599. Composition of Tobacco.—The mean composition of some of the more important varieties of water-free tobacco is shown in the following table:[617]
| Havana, per cent. |
Sumatra, per cent. |
Kentucky, per cent. |
Java, per cent. |
|
|---|---|---|---|---|
| Nicotin | 3.98 | 2.38 | 4.59 | 3.30 |
| Malic acid | 12.11 | 11.11 | 11.57 | 6.04 |
| Citric acid | 2.05 | 2.53 | 3.40 | 3.30 |
| Oxalic acid | 1.53 | 2.97 | 2.03 | 3.38 |
| Acetic acid | 0.42 | 0.29 | 0.43 | 0.22 |
| Tannic acid | 1.13 | 0.98 | 1.48 | 0.51 |
| Nitric acid | 1.32 | 0.60 | 1.88 | 0.23 |
| Pectic acid | 11.36 | 11.88 | 8.22 | 10.13 |
| Cellulose | 15.76 | 10.59 | 12.48 | 11.82 |
| Ammonia | 0.49 | 0.06 | 0.19 | 0.23 |
| Soluble nitrogenous matter | 7.74 | 8.84 | 13.90 | 10.39 |
| Insoluble”” | 9.75 | 7.97 | 8.10 | 9.53 |
| Residue and chlorophyll | 5.15 | 8.63 | 1.99 | 6.45 |
| Oil | 1.03 | 1.26 | 2.28 | 0.81 |
| Ash | 17.50 | 17.03 | 14.36 | 18.46 |
| Undetermined | 8.68 | 12.88 | 13.10 | 15.20 |
[Pg 599] Among the undetermined matters are included those of a gummy or resinous composition not extracted by ether, the exact nature of which is not well understood, and the starches, sugars, pentosans and galactan.
Tobacco grown in more northern latitudes has less nicotin than the samples given in the foregoing table.
The following table shows the composition of tobacco grown in Connecticut:[618]
| Upper leaves. | Short seconds. | First wrappers. | ||||
|---|---|---|---|---|---|---|
| (A) % |
(B) % |
(A) % |
(B) % |
(A) % |
(B) % |
|
| Water | 23.50 | 23.40 | 27.40 | 21.10 | 27.50 | 24.90 |
| Pure ash | 14.89 | 15.27 | 22.85 | 25.25 | 15.84 | 16.22 |
| Nicotin | 2.50 | 1.79 | 0.77 | 0.50 | 1.26 | 1.44 |
| Nitric acid | 1.89 | 1.97 | 2.39 | 2.82 | 2.59 | 2.35 |
| Ammonia | 0.67 | 0.71 | 0.16 | 0.16 | 0.33 | 0.47 |
| Proteids | 12.19 | 13.31 | 6.69 | 6.81 | 11.31 | 11.62 |
| Fiber | 7.90 | 8.78 | 7.89 | 8.95 | 9.92 | 10.42 |
| Starch | 3.20 | 3.36 | 2.62 | 3.01 | 2.89 | 3.08 |
| Oil and fat | 3.87 | 3.42 | 2.95 | 3.04 | 2.84 | 2.92 |
| Undeterm’d | 29.39 | 27.99 | 26.28 | 28.36 | 25.52 | 26.88 |
600. Estimation of Water.—In the estimation of water in vegetable substances, as has already been noted, it is usual to dry them in the air or partial vacuum, or in an inert gas, at a temperature of 100° until a constant weight is reached. By this process, not only the water, but all substances volatile at the temperature and in the conditions mentioned are expelled. The quantity of these volatile substances in vegetable matter, as a rule, is insignificant and hence the total loss may be estimated as water. In the case of tobacco a far different condition is presented, inasmuch as the nicotin, which sometimes amounts to five per cent of the weight of the sample, is also volatile under the conditions mentioned. It is advisable, therefore, to dry the sample of tobacco at a temperature not above fifty degrees and in a vacuum as complete as possible. Tobacco is also extremely rich in its content of crystallized mineral salts, containing often water of crystallization, and there is danger of this crystal water being lost when the sample is dried at 100°. The desiccation is conveniently made in the apparatus described on page 22. If a high vacuum be employed, [Pg 600] viz., about twenty-five inches of mercury, it is better not to allow the temperature to go above 40° or 45°. A rather rapid current of dry air should be allowed to pass through the apparatus for the more speedy removal of the moisture and a dish containing sulfuric acid may also be placed inside of the drying apparatus. It is possible by proceeding in this way to secure constant weight in the sample after a few hours.
601. Estimation of Nitric Acid.—The nitric acid in a sample of tobacco is most easily estimated by the ferrous chlorid process.[619]
The sample is best prepared by making an alcoholic extract which is accomplished by exhausting about twenty-five grams of the fine tobacco powder with 200 cubic centimeters for forty per cent alcohol made slightly alkaline by soda lye. The mixture is boiled in a flask with a reflux condenser for about an hour. After cooling, the volume is completed to a definite quantity, and, after filtering, an aliquot part is used for the analytical process. It is evident that the nitric acid cannot be estimated in this case after previous reduction to ammonia by zinc or iron on account of the presence of ammonia in the sample itself. If, however, the amount of ammonia be determined in a separate portion of the sample, the nitric acid may be reduced in the usual way, by zinc or iron, the total quantity of ammonia determined by distillation, the quantity originally present in the sample deducted and the residual ammonia calculated to nitric acid.
602. Sulfuric and Hydrochloric Acids.—These two acids are determined in the ash of the sample by the usual methods. The sulfuric acid thus found represents the original sulfuric acid in combination with the bases in the mineral parts of the plant, together with that produced by the oxidation of the organic sulfur during combustion. In order to avoid all loss of sulfur during the combustion, the precautions already given should be observed. The separation of the sulfur pre-existing as sulfates from that converted into sulfates during the combustion is accomplished as previously directed.[620] For ordinary purposes, this separation is not necessary.
To avoid loss of chlorin from volatilization during incineration the [Pg 601] temperature should be kept at the lowest possible point until the mass is charred, the soluble salts extracted from the charred mass and the incineration completed as usual.
603. Oxalic, Citric and Malic Acids.—The separation and estimation of organic acids from vegetable tissues is a matter of great difficulty, especially when they exist as is usually the case, in very minute proportions. During incineration, the salts of the inorganic acids are converted into carbonates and the subsequent examination of the ash gives no indication of the character of the original acids. In the case of tobacco, the organic acids of chief importance, from an analytical point of view, are oxalic, citric and malic. These acids may be extracted and separated by the following process:[621]
Ten grams of the dry tobacco powder are rubbed up in a mortar with twelve cubic centimeters of dilute sulfuric acid (one to five) and then absorbed with coarse pumice stone powder in sufficient quantity to cause all the liquid to disappear. The mass is placed in an extraction apparatus of proper size and thoroughly extracted with ether until a drop of the extract leaves no acid residue on evaporation. Usually about ten hours are required. The organic acids are thus separated from the mineral acids. The ether is removed from the extract and the residue dissolved in hot water, cooled, filtered, if necessary several times, until the solution is separated from the fat and resin which have been extracted by the ether. The filtrate is neutralized with ammonia, slightly acidified with acetic and the oxalic acid contained therein thrown out by means of a dilute solution of calcium acetate, which must not be added in excess. The calcium oxalate is separated by filtration, and determined as lime oxid. To the filtrate is added drop by drop, with constant stirring, a dilute solution of lead acetate, prepared by mixing one part of a saturated solution of lead acetate with four parts of water. When the precipitate formed has settled, the clear supernatant liquid is tested by adding a drop of acetic acid and a few drops of the dilute lead acetate. In case a precipitate be formed, the addition of the lead acetate is continued until a precipitate is secured which will immediately dissolve in acetic acid. [Pg 602] At this moment the citric acid is almost completely precipitated. In order to avoid the accumulation of the acetic acid by reason of the repetition of the process as above described, the mixture is neutralized each time with dilute ammonia. The precipitated neutral lead citrate obtained by the above process, is separated by filtration and, in order to avoid its decomposition when washed with pure water, it is washed with a very dilute acetic acid solution of lead acetate. The washing and filtration are accomplished as quickly as possible, and the final washing is made with alcohol of thirty-six per cent strength. In the filtrate the residual lead citrate, together with a little lead malate, are precipitated by the alcohol used as the wash and this precipitate is also separated by filtration. The filtrate containing the greater part of the malic acid is evaporated to remove the alcohol and treated with lead acetate in excess. Afterwards it is mixed with five times its volume of thirty-six per cent alcohol containing a half per cent of acetic acid. In these conditions the lead malate is completely precipitated as neutral salt, and after standing a few hours, is separated by filtration. The three precipitates, obtained as above, are dried at 100° and weighed. If the precipitates have been collected on filter paper they should be removed as completely as possible, the papers incinerated in the usual way and any reduced lead converted into nitrate and oxid by treatment with nitric acid and subsequent ignition. From the quantities of lead oxid obtained, the weights of the citric and malic acids are computed. The precipitate which is obtained by the action of alcohol, above noted, is also dried and ignited and the lead oxid found divided equally between the citric and malic acids, the respective quantities of which found, are included in computing their total weights. The weight of the citric acid is calculated from the formula (C₆H₅O₇)₂Pb₃ + H₂O, and that of the malic acid from the formula C₄H₄O₅Pb + H₂O.
604. Acetic Acid.—For the determination of the volatile acids of the fatty series existing in tobacco, the following process, also due to Schlösing, may be followed:[622]
The apparatus employed is shown in Fig. 121. Ten grams of the pulverized [Pg 603] tobacco, moistened with water and mixed with a little powdered tartaric acid, are placed in the tube A. The two ends of the tube, A, are stoppered with asbestos or glass wool. Steam, generated in the flask, D, is passed into B. After fifteen minutes, or as soon as it is certain that the contents of A have reached a temperature of 100°, the dish, F, containing mercury, is placed in the position shown in the figure. The steam, by this arrangement, is forced into the lower end of A, passes into the condenser E, and the condensed water collected in C. The operation should be so conducted as to avoid any condensation of water in B. It is advisable during the progress of the distillation, which should continue for at least twenty minutes, to neutralize from time to time the acetic acid collected in C by a set solution of dilute alkali, or, an excess of the alkaline solution may be placed in C and the part not neutralized by the acetic acid determined at the end of the distillation by titration.

Fig. 121.—Apparatus for Acetic Acid.
605. Pectic Acid.—Under this term are included not only the pectic acid but all the other bodies of a pectose nature contained in tobacco. These bodies are of considerable interest, although they do not belong to the most important constituents. In fresh tobacco leaves are found three pectin bodies. One pectin is soluble in water, another is an insoluble pectose and the third is the pectose body forming salts with the alkalies, i. e., true pectic acid. In fermented tobacco pectic acid is found chiefly in combination with lime in the ribs of the leaves, serving to give them the necessary stiffness. For the estimation of the pectin bodies (mucilage) the powdered tobacco is [Pg 604] thoroughly extracted with cold water. An aliquot part of the aqueous extract is mixed with two volumes of strong alcohol and allowed to stand in a well closed vessel in a cool place for twenty-four hours. The precipitate is collected on a filter, washed with sixty-six per cent alcohol, dried and weighed. The dried residue is incinerated and the amount of ash determined. In general, vegetable mucilages contain about five per cent of ash. If more than this be found, it is due to the solution of the salts of the organic acids contained in the sample. A dried vegetable mucilage, obtained as above, dissolves in water to a mucilaginous liquid which does not reduce alkaline copper solution until it has been hydrolyzed by boiling with a dilute mineral acid.[623]
606. Tannic Acid.—This acid is separated and estimated by the processes given in paragraphs 589-595.
607. Starch and Sugar.—The unfermented leaves of tobacco contain considerable quantities of carbohydrates in addition to woody fiber, pentosans, galactan and cellulose. Among these, starch is the most important. Sugar exists in small quantities in the fresh leaf, usually not over one per cent. During fermentation, according to some authorities, the starch is partially converted into sugar and the latter substance disappears under the action of the alcoholic ferments. It has been found at the Connecticut Station, however, that the starch content of the leaf does not decrease during fermentation. The starch and sugar may be determined in the fresh leaves by the methods already given.
In the manufacture of certain grades of tobacco it is customary to add a quantity of sugar. The analyst may thus be called upon to determine in some cases whether the sugar found in a sample is natural or added. The occurrence of natural sugars in tobacco has been investigated at the instance of the British Treasury.[624]
The natural sugars which may be found in sun dried tobaccos usually disappear entirely during the process of fermentation. It was found by the Somerset House chemists that the content of sugar in commercial tobaccos varies from none at all to over fifteen per cent. A remarkable example of this variation is reported in two samples from this country, [Pg 605] one of which, grown in Kentucky, contained no sugar, and the other grown in Virginia, 15.2 per cent.
It was noticed that the saccharin matters in the tobaccos examined were neutral to polarized light. They are determined by their copper reducing power. The tobacco sugars are therefore to be classed with the reducing bodies, not optically active, found in the juices of sorghum and sugar canes.
608. Ammonia.—As has already been intimated, ammonia exists only in minute quantities in fresh tobacco leaves, but in considerable quantities after fermentation. In the estimation of ammonia, twenty grams of the tobacco powder are digested with 250 cubic centimeters of water, acidulated with sulfuric and after an hour enough water added to make the total quantity 400 cubic centimeters. After filtration, an aliquot part of the filtrate, about 200 cubic centimeters, is treated with magnesium oxid in excess and the ammonia and nicotin removed by distillation in a current of steam. The distillate is collected in dilute sulfuric acid of known strength. The total amount of the two bases is determined by titration and the quantity of base representing the nicotin, which has been determined in a separate sample, subtracted in order to obtain the weight of the ammonia.[625]
The ammonia in tobacco is determined by Nessler in the following manner:[626]
The powdered tobacco is mixed with water and magnesium oxid and after standing for several hours it is distilled in a current of steam, the distillate received in dilute sulfuric acid and the process continued until a drop of the distillate gives no reaction for ammonia with the nessler reagent. The excess of sulfuric acid in the distillate is neutralized with pure sodium carbonate and the nicotin precipitated by a neutral solution of mercuric iodid and potassium iodid. The precipitate is separated by filtration, the filtrate treated with sodium sulfid, and the ammonia again obtained by distillation with an alkali, collected in dilute solution of set sulfuric acid and determined by titration. The difference of the two determinations represents the ammonia.
609. Nicotin.—In this laboratory McElroy has made a study of [Pg 606] some of the best approved methods for determining nicotin, and finds the most simple and reliable to be that proposed by Kissling.[627] The finely powdered tobacco should be dried at a temperature not exceeding 60°, or it may be partially dried at that temperature before grinding and the final drying completed afterwards. Twenty grams of the powdered sample are intimately mixed by means of a pestle with ten cubic centimeters of dilute alcoholic solution of soda lye, made by dissolving six grams of sodium hydroxid in forty cubic centimeters of water and completing the volume to 100 cubic centimeters with ninety-five per cent alcohol. The mass is transferred to an extraction paper cylinder, placed in an extraction apparatus and extracted for three hours with ether. The ether is nearly all removed by careful distillation, the residue mixed with fifty cubic centimeters of a very dilute soda lye solution (4 to 100) and subjected to distillation in a current of steam. The flask containing the nicotin extract should be connected with the condensing apparatus by a safety bulb as is usual in the distillation of substances containing fixed alkali. The distillation should be conducted rapidly and in such a manner that when 200 cubic centimeters of the distillate have been collected, not more than fifteen cubic centimeters of the liquid remain in the distillation flask. In the distillate, the nicotin is determined by titration with a set solution of dilute sulfuric acid, using rosolic acid or phenacetolin as indicator. It is advisable to titrate each fifty cubic centimeters of the distillate as it is received and the distillation is continued until the last fifty cubic centimeters give no appreciable quantity of the alkaloid. In the calculations one molecule of sulfuric acid is equivalent to two molecules of nicotin according to the equation
Polarization Method.—Popovici has based a method of detecting the quantity of nicotin in tobacco on its property of rotating the plane of polarized light.[628] The gyrodynat of pure nicotin is expressed by the formula [a]D = -161°.6. When ten parts of nicotin are mixed with ninety parts of water, this value becomes -74°.1. By reason of this great depression in gyrodynatic value [Pg 607] Popovici determined the relation which exists between the dilute solutions of nicotin and the number of minutes of angular rotation produced on polarization in a 200 millimeter tube. In a solution in which two grams of nicotin are contained in fifty cubic centimeters, each minute of angular rotation is found to correspond to 6.5 milligrams of nicotin. For one gram in solution in the same volume one minute of angular rotation corresponds to 5.9 milligrams and for a half gram in solution to 5.7 milligrams.
The nicotin is prepared for polarization by extracting with ether, as indicated in the previous paragraph, and the ethereal solution from twenty grams of tobacco is shaken with a concentrated solution of sodium phosphotungstate in nitric acid by means of which nicotin and ammonia are precipitated and rapidly settle. The supernatant liquid is carefully poured off and the residue made up to a volume of fifty cubic centimeters with distilled water and the nicotin freed from any of its compounds by the addition of eight grams of finely powdered barium hydroxid. In order to promote the decomposition of the nicotin compounds the mixture should be shaken at intervals for several hours. The at first blue precipitate changes into blue green and finally into yellow. It is separated by filtration and the somewhat yellow colored filtrate placed in an observation tube, polarized, the polarization calculated to minutes of angular rotation and the number of minutes thus found multiplied by the nearest factor given above.
The analyst will find a description of other methods of estimating nicotin in tobacco in the periodical literature of analytical chemistry.[629]
610. Estimation of Amid Nitrogen.—For the estimation of amid nitrogen ten grams of the powdered tobacco are digested with 100 cubic centimeters of forty per cent alcohol, the extract separated by filtration, acidified with sulfuric and the albumin, peptone, nicotin and ammonia precipitated with as little phosphotungstic acid as possible. The precipitate is separated by filtration and seventy-five cubic centimeters of the filtrate evaporated in a thin glass or tin foil capsule after the addition of a little barium chlorid and the nitrogen determined in the residue. The nitrogen thus obtained is that [Pg 608] which was present in an amid state. The nitrogen present as amids, ammonia and nicotin subtracted from the total nitrogen leaves that present as protein.
611. Fractional Extraction of Tobacco.—To determine the character of the soluble constituents of tobacco it is advisable to subject it to a fractional extraction with different reagents. The reagents usually employed in the order mentioned are petroleum ether, ether, absolute alcohol, water, dilute soda lye and dilute hydrochloric acid. The extract obtained by petroleum ether contains vegetable wax, chlorophyll and its alteration products, fat, ethereal oils, and resin bodies. The extract with ether may be divided into water soluble and alcohol soluble bodies. Among the first are small quantities of glucosids and nicotin while in the alcoholic solution resin predominates.
The alcoholic extract is also divided into water soluble and alcohol soluble parts. The first contains the nicotin, which is insoluble in ether, in combination with acids, together with tannic acid and allied bodies and also the sugar. The part insoluble in water consists chiefly of resin.
The aqueous solution contains the vegetable mucilages (pectin) soluble carbohydrates, soluble proteids and organic acids.
The dilute soda lye solution contains chiefly proteids.
The dilute hydrochloric acid solution contains the starch and the oxalic acid originally combined with lime. The extractions with dilute soda lye and dilute hydrochloric acid should be made at a boiling temperature. The residual matter consists of a mixture of carbohydrate bodies to which the term crude fiber is usually applied.
612. Burning Qualities.—When tobacco is to be used for the manufacture of cigars, or cigarettes, or for smoking in pipes, its ability to keep burning is a matter of great importance. The tobacco, when once ignited, should burn for some time and form, a fluffy ash, free of fused mineral particles. A tobacco with good burning properties is one containing nitrates in considerable quantity, not too much sugar and starch, a porous cellular structure and comparatively free of chlorin. In determining comparative burning properties the tests may be [Pg 609] applied to the single leaf or the tobacco may be first rolled into a cigar form and burned in an artificial smoker.

Fig. 122.
Apparatus for Smoking.
In applying the test to the leaf it is important that the ignition be made with a fuse without flame, which maintains a uniform burning power. Any good slow burning fuse may be used and it is applied to the leaf in such a way that a hole may be burned in it, leaving its edges uniformly ignited. The number of seconds elapsing before the last spark is extinguished is noted. At the Connecticut Experiment Station a lighter, proposed by Nessler, is employed. It is prepared by digesting eighty grams of gum arabic in 120 cubic centimeters, and forty grams of gum tragacanth in a quarter of a liter of water for two days, mixing the mucilaginous masses and adding ten grams of potassium nitrate and about 350 grams of pulverized charcoal. The mixture is rolled, on a plate sprinkled with charcoal, into sticks a few inches in length and of the diameter of a cigar and dried at a gentle heat. These fuses burn slowly and without smoke and are well suited for lighting tobacco leaves. Several tests, at least six, should be made with each leaf. Leaves having a uniform burning power should be used as comparators and the number of seconds they burn be designated by 100. It is important that all the samples to be tested be exposed for a day or two to the same atmosphere in order that they may have, as nearly as possible, the same content of moisture. The burning tests, when possible, should be made both before and after fermentation. As a rule fermentation improves the burning quality of second rate leaves, but has little effect on leaves of the first quality.
613. Artificial Smoker.—For the purpose of comparing the burning properties of cigars, or of leaves rolled into cigar form, the artificial smoking apparatus devised by Penfield and modified in this laboratory is employed.[630] The construction of the apparatus is shown in the accompanying figure.
The lighted cigar is set in the tube at the left, so that air entering [Pg 610] the test-tube must pass through the cigar. The test-tube contains enough water to seal the end of the tube carrying the cigar, and is connected with the aspirator on the right by the T tube, as shown. An arm of the T dips just beneath the surface of the liquid in the cup in the center. Water flows in a slow stream into the aspirator through the tube at the extreme right, forcing the air out through the arm of the T until the siphon begins to act. While the water is voided through the long arm of the siphon, air enters through the cigar, the liquid rising in the T. The action of the apparatus is automatic and intermittent. When the cigar is about one-third burned, it is removed without disturbing the ash cone, and the latter examined and compared with other samples as a standard. The sealing liquid of the long arm of the T may be mercury or water. In case mercury be used, care must be taken not to immerse the open end of the T more than one millimeter therein.
614. Description.—Among fermented beverages are included those drinks, containing alcohol, prepared by fermenting the sugars or starches of fruits, cereals or other agricultural products. Wine and beer, in their various forms, and cider are the chief members of this class of bodies. Koumiss, although a fermented beverage, is not included in this classification, having been noticed under dairy products. The large number of artificial drinks, made by mixing alcohol with fruit and synthesized essences, is also excluded, although the methods of analysis which are used may be applied also to them.
Fermented beverages containing less than two per cent of alcohol are [Pg 611] usually regarded as non-intoxicating drinks. Beers are of several varieties, and the term includes lager beer, ale, porter and stout. Distilled liquors are obtained by separating the alcohols and other volatile matters from the products of fermentation by distillation. It is not practicable here to attempt a description of the methods of preparing fermented drinks. Special works on this branch of the subject are easy of access.[631]
615. Important Constituents.—Alcohol is the most important constituent of fermented beverages. The solid matters, commonly called extract, which are obtained on evaporation are composed of dextrins, sugars, organic acids, nitrogenous bodies and mineral matters affording ash on combustion. Of these the dextrins and sugars form the chief part and the proteid bodies nearly ten per cent in the case of beers made of malt and hops. In beers the bitter principles derived from hops, while not important by reason of quantity, are of the utmost consequence from a gustatory and hygienic point of view. The ash of fermented beverages varies with their nature, or with the character of the water used in making the mash. In the manufacture of beer, water containing a considerable proportion of gypsum is often used, and this substance is sometimes added in the course of manufacture, especially of wine. The presence of common salt in the ash in any notable quantity is evidence of the addition of this condiment, either to improve the taste of the beverage or to increase the thirst of the drinker. In cider the organic acids, especially malic, are of importance.
Glycerol is a product of fermentation and of the hydrolysis of the fats and oils in the substances fermented.
616. Specific Gravity.—In order to secure uniformity of expression, the specific gravity of fermented beverages is determined at about 15°.6, although that is a temperature much below the average found in American laboratories. The specific gravity may be determined by an alcoholometer, pyknometer or hydrostatic balance in harmony with the directions given in paragraphs 48-54 and 285. By reason of the extractive matters held in solution, fermented beverages are usually heavier than water, even if the content of alcohol be twenty per cent or more. On the other hand distilled liquors are lighter than water. [Pg 612]
617. Determination of Alcohol.—The determination of the percentage of alcohol present in a solution is based on two general principles. On the one hand, and this is the base of the methods in common use, the alcohol is secured mixed only with water and its amount determined by ascertaining the specific gravity of the mixture. On the other hand the quantity of alcohol in a mixture may be determined by ascertaining the temperature of the vapors produced on boiling. This is the principle involved in the use of the ebullioscope. The latter method is not employed to any extent in this country.
Use of the Alcoholometer.—The alcoholometer usually employed is known by the name of Gay-Lussac, who first made practical use of it in the determination of alcohol. It is constructed in such a way as to read directly the volume of absolute alcohol contained in one hundred volumes of the liquid at a temperature of 15°.6. The instruments employed should be carefully calibrated and thoroughly cleaned by washing with absolute alcohol before use. The stem of the instrument must be kept free from any greasy substance, and this is secured by washing it with ether. After this last washing the analyst should be careful not to touch the stem of the instrument with his fingers. It is most convenient to make the determination exactly at 15°.6, but when made at other temperatures the reading of the instrument is corrected by tables which may be found in works especially devoted to the analysis of wines.[632]
In this country the alcoholometer is used to some extent, but the official method is based upon the determination of the specific gravity by an instrument constructed in every respect like the alcoholometer, but giving the specific gravity of the liquor at 15°.6 instead of its percentage by volume in alcohol. The reading of the instrument having been determined at a temperature of 15°.6, the corresponding percentage of alcohol by volume or by weight is taken directly from the table given further on.

Fig. 123. Metal Distilling Apparatus.
Methods of Distillation.—The metal apparatus employed in the laboratory of the Department of Agriculture, for the distillation of fermented beverages in order to determine the percentage of alcohol by [Pg 613] the method given above, is shown in the accompanying figure. The apparatus consists of a retort of copper carried on supports in such a way as to permit an alcohol or bunsen lamp to be placed under it. It is connected with a block tin condenser and the distillate is received in a tall graduated cylinder placed under the condenser in such a way as to prevent the loss of any alcohol in the form of vapor. Exactly 300 cubic centimeters of the wine or fermented beverage are used for the distillation. Any acid which the wine contains is first saturated with calcium carbonate before placing in the retort. Exactly 100 cubic centimeters of distillate are collected and the volume of the distillate is completed to 300 cubic centimeters by the addition of recently distilled water.[633] The cylinder containing the distillate is brought to a temperature of 15°.6, the alcoholometer inserted and its reading taken with the usual precautions.
Official Method.—The alcoholometers employed in the official methods are calibrated to agree with those used by the officers of the Bureau of Internal Revenue. They are most conveniently constructed, carrying the thermometer scale in the same stem with that showing the specific gravity. It is highly important that the analyst assure himself of the exact calibration of the instrument before using it. Inasmuch as the volume of the distillate may not be suited in all cases to the use of a large alcoholometer, it is customary in this laboratory to determine the specific gravity by means of the hydrostatic balance, as described further on. Attention is also called to the fact that, in the official method, directions are not given to neutralize the free acid of the fermented beverage before the distillation. Since the Internal Revenue Bureau is concerned chiefly with the determination of alcohol in distilled liquors, this omission is of little consequence. Even in ordinary fermented beverages the percentage of volatile acids, (acetic etc.,) is so small as to make the error due to the failure to [Pg 614] neutralize it of but little consequence. In order, however, to avoid every possibility of error, it is recommended that in all instances the free acids of the sample be neutralized before distillation. In this laboratory, the distillations are conducted in a glass apparatus shown in the accompanying figure. The manipulation is as follow:[634]

Fig. 124. Distilling Apparatus.
One hundred cubic centimeters of the liquor are placed in a flask of from 250 to 300 cubic centimeters capacity, fifty cubic centimeters of water added, the flask attached to a vertical condenser by means of a bent bulb tube, 100 cubic centimeters distilled and the specific gravity of the distillate determined. The distillate is also weighed, or its weight calculated from the specific gravity. The corresponding percentage of alcohol by weight is obtained from the appended table, and this figure multiplied by the weight of the distillate, and the [Pg 615] result divided by the weight of the sample, gives the per cent of alcohol by weight contained therein.
The percentage of alcohol by volume of the liquor is the same as that of the distillate, and is obtained directly from the appended table.
In distilled liquors about thirty grams are diluted to 150 cubic centimeters, 100 cubic centimeters distilled and the per cent of alcohol by weight determined as above.
The percentage of alcohol by volume in the distillate is obtained from the appended table. This figure divided by the number expressing the volume in cubic centimeters of the liquor taken for the determination (calculated from the specific gravity), and the result multiplied by 100 gives the per cent of alcohol by volume in the original liquor.
618. Determining the Specific Gravity of the Distillate.—The specific gravity of the distillate may be determined by the pyknometer, alcoholometer, hydrostatic balance or in any accurate way. The volume of the distillate is not always large enough to be conveniently used with an alcoholometer, especially the large ones employed by the Bureau of Internal Revenue. In the laboratory of the Agricultural Department, it is customary to determine the density of the distillate by the hydrostatic balance shown in paragraph 285. The specific gravity is in each case determined at 15°.6, referred to water of the same temperature, or if at a different temperature calculated thereto.
619. Table for Use with Hydrostatic Plummet.—It is more convenient to determine the density of the alcoholic distillate at room temperature than to reduce it to the standard for which the plummet is graduated. In the case of a plummet which displaces exactly five grams, or multiple thereof, of distilled water at 15°.6, the corrections for temperatures between 12°.2 and 30° are found in the following table, prepared by Bigelow.[635]
If the weight of the alcoholic solution displaced be 4.96075 grams the apparent specific gravity 0.99215 and the temperature of observation 25°.4, the correction, which is additive, as given in the table is 0.00191 and the true specific gravity is 0.99406 and the percentage of alcohol by volume 4.08. [Pg 616]
When the plummet does not exactly displace five grams of water at 15°.6, but nearly so, the table may still be used.
For example, suppose the weight of water displaced be 4.9868 instead of five grams. The apparent specific gravity of the water by this plummet is 0.99736 and the difference between this and the true specific gravity is 0.00264, which is a constant correction to be added to the specific gravity as determined in each case.
Correction Table for Specific Gravity.
Below 15°.6 Subtract; Above 15°.6 Add.
| Temp. | Correction. | Temp. | Correction. | Temp. | Correction. |
|---|---|---|---|---|---|
| 12.2 | 0.00047 | 18.2 | 0.00043 | 24.2 | 0.00163 |
| 12.4 | 0.00044 | 18.4 | 0.00046 | 24.4 | 0.00167 |
| 12.6 | 0.00042 | 18.6 | 0.00050 | 24.6 | 0.00172 |
| 12.8 | 0.00039 | 18.8 | 0.00053 | 24.8 | 0.00176 |
| 13.0 | 0.00037 | 19.0 | 0.00057 | 25.0 | 0.00181 |
| 13.2 | 0.00634 | 19.2 | 0.00061 | 25.2 | 0.00186 |
| 13.4 | 0.00032 | 19.4 | 0.00065 | 25.4 | 0.00191 |
| 13.6 | 0.00029 | 19.6 | 0.00068 | 25.6 | 0.00195 |
| 13.8 | 0.00027 | 19.8 | 0.00072 | 25.8 | 0.00200 |
| 14.0 | 0.00024 | 20.0 | 0.00076 | 26.0 | 0.00205 |
| 14.2 | 0.00021 | 20.2 | 0.00080 | 26.2 | 0.00210 |
| 14.4 | 0.00018 | 20.4 | 0.00084 | 26.4 | 0.00215 |
| 14.6 | 0.00015 | 20.6 | 0.00087 | 26.6 | 0.00220 |
| 14.8 | 0.00012 | 20.8 | 0.00091 | 26.8 | 0.00225 |
| 15.0 | 0.00009 | 21.0 | 0.00095 | 27.0 | 0.00230 |
| 15.2 | 0.00006 | 21.2 | 0.00099 | 27.2 | 0.00235 |
| 15.4 | 0.00003 | 21.4 | 0.00103 | 27.4 | 0.00240 |
| 15.6 | 0.00000 | 21.6 | 0.00107 | 27.6 | 0.00246 |
| 15.8 | 0.00003 | 21.8 | 0.00111 | 27.8 | 0.00251 |
| 16.0 | 0.00006 | 22.0 | 0.00115 | 28.0 | 0.00256 |
| 16.2 | 0.00009 | 22.2 | 0.00119 | 28.2 | 0.00261 |
| 16.4 | 0.00012 | 22.4 | 0.00123 | 28.4 | 0.00267 |
| 16.6 | 0.00016 | 22.6 | 0.00128 | 28.6 | 0.00272 |
| 16.8 | 0.00019 | 22.8 | 0.00132 | 28.8 | 0.00278 |
| 17.0 | 0.00022 | 23.0 | 0.00136 | 29.0 | 0.00283 |
| 17.2 | 0.00025 | 23.2 | 0.00140 | 29.2 | 0.00288 |
| 17.4 | 0.00029 | 23.4 | 0.00145 | 29.4 | 0.00294 |
| 17.6 | 0.00032 | 23.6 | 0.00149 | 29.6 | 0.00299 |
| 17.8 | 0.00036 | 23.8 | 0.00154 | 29.8 | 0.00306 |
| 18.0 | 0.00039 | 24.0 | 0.00158 | 30.0 | 0.00311 |
The table is only accurate when the distillate does not contain over seven nor less than three per cent of alcohol. If the distillate contain more than seven per cent of alcohol it is diluted and the compensating correction made.
620. Calculating Results.—The specific gravity of the alcoholic distillate having been determined by any approved method and corrected to a temperature of 15°.6, the corresponding per cents of alcohol by volume and by weight are found by consulting the following table.[636] If, for example, the corrected specific gravity be exactly that given in any figure of the table the corresponding per cents are directly read. If the specific gravity found fall between two numbers in the table the corresponding per cents are determined by interpolation. [Pg 617]
Table Showing Percentage of Alcohol
by Weight and by Volume.
[Pg 622] 621. Determination of Percentage of Alcohol by Means Of Vapor Temperature.—The temperature of a mixture of alcohol and water vapors is less than that of water alone and the depression is inversely proportional to the quantity of alcohol present. This principle is utilized in the construction of the ebullioscope or ebulliometer. In this apparatus the temperature of pure boiling water vapor is determined by a preliminary experiment. This point must be frequently revised in order to correct it for variations in barometric pressure. The water is withdrawn from the boiler of the apparatus, the same volume of a wine or beer placed therein, and the vapor temperature again determined. By comparing the boiling point of the wine, with a scale calibrated for different percentages of alcohol, the quantity of spirit present is determined. When water vapor is at 100° a vin ordinaire having eight per cent of alcohol gives a vapor at 93°.8. The presence of extractive matters in the sample, which tend to raise its boiling point, is neglected in the calculation of results.
622. Improved Ebullioscope.—The principle mentioned in the above paragraph may be applied with a considerable degree of accuracy, by using the improved ebullioscope described below.[637]
The apparatus consists of a glass flask F, shaped somewhat like an erlenmeyer, closed at the top with a rubber stopper carrying a central aperture for the insertion of the delicate thermometer A B, and a lateral smaller aperture for connecting the interior of the flask with the condenser D. The return of the condensed vapors from D is effected through the tube entering the flask F in such a manner as to deliver the condensed liquid beneath the surface of the liquid in F as shown in the figure. The flask F contains pieces of scrap platinum or pumice stone to prevent bumping and secure an even ebullition. The flask F rests upon a disk of asbestos, perforated in such a way as to have the opening fully covered by the bottom of the flask. To protect F against the influence of air currents it is enclosed in the glass cylinder E resting on the asbestos disk below and closed with a detachable soft rubber cover at the top. The temperature between the cylinder E and the [Pg 623] flask F is measured by the thermometer C and the flame of the lamp G should be so adjusted as to bring the temperature between the flask F and the cylinder E to about 90° at the time of reading the thermometer B. The bulb of the thermometer B may be protected by a thin glass tube carrying distilled water, so adjusted as to prevent the escape of the watery vapor into F. The thermometer B is such as is used for determining molecular weights by the cryoscopic method. It has a cistern at A which holds any excess of mercury not needed in adjusting the thermometer for any required temperature.

Fig. 125. Improved Ebullioscope.
A second apparatus, exactly similar to the one described, is conveniently used for measuring the changes in barometric pressure during the process of the analysis. The temperature of the vapor of boiling water having been first determined, the beer or wine is placed in F, and the temperature of the vapor of the boiling liquid determined after the temperature of the air layer between E and F reaches about 90°, measured on the thermometer C. By using alcoholic mixtures of known strength the depression for each changing per cent of alcohol is determined for each system of apparatus employed, and this having once been done, the percentage of alcohol in any unknown liquid is at once determined by inspecting the thermometer, the bulb of which [Pg 624] is immersed in the vapor from the boiling liquid. In the apparatus figured, a depression of 0°.8 is equivalent to one per cent of alcohol by volume. Full directions for the manipulation of the apparatus may be found in the paper cited above.
623. Total Fixed Matters.—The residue left on evaporating a fermented beverage to dryness is commonly known as extractive matter, or simply extract. It is composed chiefly of unfermented carbohydrates, organic acids, nitrogenous bodies, glycerol and mineral substances. Hydrochloric and sulfuric acids may also be found therein. If any non-volatile preservatives have been used in the sample, such as borax, salicylates and the like, these will also be found in the solid residue. The bodies which escape are water, alcohols, ethers and essential oils. The character of the residue left by wines and beers is evidently different. In each case it should contain typical components which aid in judging of the purity of the sample. For instance, in beers the substitution for malt of carbohydrate bodies comparatively free of proteids, produces a beer containing a deficiency of nitrogenous bodies. Pure malt beer will rarely have less than one-half of a per cent of proteids, while beer made largely of glucose, rice or hominy grits, will have a much smaller quantity. First will be described below the methods of determining the fixed residue left on evaporation, and thereafter the processes for ascertaining its leading components.
624. Methods of the Official Chemists.—Two methods are in use by the official chemists for determining the fixed solids in fermented beverages.[638] They are as follows:
Direct Method.—Fifty cubic centimeters of the sample are weighed, placed in a platinum dish about eighty millimeters in diameter and capable of holding about seventy-five cubic centimeters and evaporated on the steam bath to a sirupy consistence. The residue is heated for two and a half hours in a drying oven at the temperature of boiling water and weighed.
In Sweet Wines.—Ten cubic centimeters of the liquor are weighed and diluted to 100 with water. Fifty cubic centimeters of this solution are evaporated as described above.
Optional Method.—Fifty cubic centimeters of the sample are placed in a platinum or porcelain dish and evaporated on the steam bath [Pg 625] until the volume is reduced to one-third. The dealcoholized liquid is washed into a fifty cubic centimeter flask, cooled and made up to the original volume. It is mixed thoroughly and the specific gravity ascertained with a pyknometer, hydrostatic balance or an accurately standardized hydrometer. The percentage of total solids is obtained from the appended table. The column on the left of the specific gravity gives the percentage of extract in a wine, as calculated by Hager, and that on the right the percentage of extract in a beer or wort, as calculated by Schultze. According to Baumert, however, Schultze’s table gives results which approximate more closely the data obtained by direct estimation than does Hager’s.
Tables of Hager and Schultze for
the Determination of Extract
by the Indirect Method.
| Hager. | Specific gravity. | Schultze. |
|---|---|---|
| 0.84 | 1.0038 | 1.00 |
| 0.86 | 1.0039 | 1.02 |
| 0.88 | 1.0040 | 1.05 |
| 0.90 | 1.0041 | 1.08 |
| 0.92 | 1.0042 | 1.10 |
| 0.94 | 1.0043 | 1.13 |
| 0.96 | 1.0044 | 1.15 |
| 0.98 | 1.0045 | 1.18 |
| 1.00 | 1.0046 | 1.21 |
| 1.02 | 1.0047 | 1.23 |
| 1.04 | 1.0048 | 1.26 |
| 1.06 | 1.0049 | 1.29 |
| 1.08 | 1.0050 | 1.31 |
| 1.10 | 1.0051 | 1.34 |
| 1.12 | 1.0052 | 1.36 |
| 1.15 | 1.0053 | 1.39 |
| 1.17 | 1.0054 | 1.41 |
| 1.19 | 1.0055 | 1.44 |
| 1.22 | 1.0056 | 1.46 |
| 1.25 | 1.0057 | 1.49 |
| 1.27 | 1.0058 | 1.51 |
| 1.30 | 1.0059 | 1.54 |
| 1.32 | 1.0060 | 1.56 |
| 1.34 | 1.0061 | 1.59 |
| 1.37 | 1.0062 | 1.62 |
| 1.39 | 1.0063 | 1.64 |
| 1.42 | 1.0064 | 1.67 |
| 1.44 | 1.0065 | 1.69 |
| 1.46 | 1.0066 | 1.72 |
| 1.48 | 1.0067 | 1.74 |
| 1.50 | 1.0068 | 1.77 |
| 1.52 | 1.0069 | 1.79 |
| 1.55 | 1.0070 | 1.82 |
| 1.57 | 1.0071 | 1.84 |
| 1.59 | 1.0072 | 1.87 |
| 1.61 | 1.0073 | 1.90 |
| 1.64 | 1.0074 | 1.92 |
| 1.66 | 1.0075 | 1.95 |
| 1.68 | 1.0076 | 1.97 |
| 1.70 | 1.0077 | 2.00 |
| 1.72 | 1.0078 | 2.02 |
| 1.75 | 1.0079 | 2.05 |
| 1.77 | 1.0080 | 2.07 |
| 1.79 | 1.0081 | 2.10 |
| 1.82 | 1.0082 | 2.12 |
| 1.84 | 1.0083 | 2.15 |
| 1.86 | 1.0084 | 2.17 |
| 1.88 | 1.0085 | 2.20 |
| 1.90 | 1.0086 | 2.23 |
| 1.92 | 1.0087 | 2.25 |
| 1.94 | 1.0088 | 2.28 |
| 1.96 | 1.0089 | 2.30 |
| 1.98 | 1.0090 | 2.33 |
| 2.00 | 1.0091 | 2.35 |
| 2.03 | 1.0092 | 2.38 |
| 2.05 | 1.0093 | 2.41 |
| 2.07 | 1.0094 | 2.43 |
| 2.09 | 1.0095 | 2.46 |
| 2.11 | 1.0096 | 2.48 |
| 2.14 | 1.0097 | 2.51 |
| 2.16 | 1.0098 | 2.53 |
| 2.18 | 1.0099 | 2.56 |
| 2.21 | 1.0100 | 2.58 |
| 2.23 | 1.0101 | 2.61 |
| 2.25 | 1.0102 | 2.64 |
| 2.27 | 1.0103 | 2.66 |
| 2.30 | 1.0104 | 2.69 |
| 2.32 | 1.0105 | 2.71 |
| 2.34 | 1.0106 | 2.74 |
| 2.36 | 1.0107 | 2.76 |
| 2.38 | 1.0108 | 2.79 |
| 2.40 | 1.0109 | 2.82 |
| 2.42 | 1.0110 | 2.84 |
| 2.44 | 1.0111 | 2.87 |
| 2.46 | 1.0112 | 2.89 |
| 2.48 | 1.0113 | 2.92 |
| 2.50 | 1.0114 | 2.94 |
| 2.52 | 1.0115 | 2.97 |
| 2.54 | 1.0116 | 2.99 |
| 2.57 | 1.0117 | 3.02 |
| 2.59 | 1.0118 | 3.05 |
| 2.61 | 1.0119 | 3.07 |
| 2.64 | 1.0120 | 3.10 |
| 2.66 | 1.0121 | 3.12 |
| 2.68 | 1.0122 | 3.15 |
| 2.70 | 1.0123 | 3.17 |
| 2.72 | 1.0124 | 3.20 |
| 2.75 | 1.0125 | 3.23 |
| 2.77 | 1.0126 | 3.25 |
| 2.79 | 1.0127 | 3.28 |
| 2.82 | 1.0128 | 3.30 |
| 2.84 | 1.0129 | 3.33 |
| 2.86 | 1.0130 | 3.35 |
| 2.88 | 1.0131 | 3.38 |
| 2.90 | 1.0132 | 3.41 |
| 2.92 | 1.0133 | 3.43 |
| 2.94 | 1.0134 | 3.46 |
| 2.96 | 1.0135 | 3.48 |
| 2.98 | 1.0136 | 3.51 |
| 3.00 | 1.0137 | 3.54 |
If it be desired to use this table for the examination of liquors containing a higher percentage of extract, Schultze’s table (intended originally for wort) may be consulted.
Gautier regards the fixed solids as the residue obtained on evaporating, in a flat platinum dish, ten cubic centimeters of wine at 100° for four hours and a half.[639]
[Pg 626] The official French method is as follows: Twenty cubic centimeters of wine are placed in a flat bottom, platinum dish of such a diameter that the depth of the liquid therein does not exceed one millimeter. The dish should be immersed as totally as possible in the steam. The heating is continued for six hours.
The following method is used at the municipal laboratory of Paris:
Twenty-five cubic centimeters of wine are placed in a flat bottom, platinum dish seventy millimeters in diameter and twenty-five deep. The dish is placed on a water bath in such a manner that it just touches the surface of the water which is kept at a constant level. The heating is continued for seven hours.[640]
625. Determination in a Vacuum.—To avoid the changes and decomposition produced by heating, the fixed solids may also be determined by drying the sample in a vacuum over sulfuric acid. In this laboratory, it has been found that the process may be greatly facilitated by connecting the desiccating apparatus with the vacuum service of the working desks in which a vacuum corresponding to a mercurial column of 600 millimeters is obtained. The desiccator is provided with a valve whereby a minute current of dry air is allowed to flow through it. This current is not large enough to lessen the vacuum but is sufficient to greatly accelerate the rapidity of the evaporation. The evaporation is hastened also, in a marked degree, by absorbing the liquid with a piece of filter paper previously dried in a vacuum. When it is desired to examine the residue, however, it must be obtained in a flat dish exposing a large surface to evaporation.
626. Estimation of Water.—It is evident that the percentage of water in a fermented beverage is easily calculated when the percentage of alcohol by weight and that of the dry residue are known. In a given case, if the number of grams of alcohol in 100 of the sample be five and that of fixed solids four and a half, the quantity of water therein is 100 - (5.0 + 4.5) = 90.5 grams. In this case the volatile essences are counted as water, but these, at most, are so small in quantity as to be practically unweighable. Nevertheless, it must be admitted that [Pg 627] direct drying, in many cases, may give erroneous results, especially when the sample contains an abundance of ethers and of glycerol. The loss which takes place on evaporation may be diminished by adding to the sample, before evaporation, a known weight of potassium sulfate in crystals, which serves to increase the surface of evaporation, to hasten the process and to obtain a quantity of residue in excess of that secured by direct evaporation in an open dish.
627. Total Acidity.—The acidity found in fermented beverages is due both to the natural acids of the materials from which they are made, and to those caused by fermentation. The typical acids also indicate the nature of the original materials, as malic in cider and tartaric in wine. The acids of beers are due almost exclusively to fermentation, and acetic is probably the dominant one. In determining total acidity, it is not always convenient to ascertain beforehand what acid predominates, nor to accurately distribute the acid among its various components. In the analytical work it is advisable, therefore, to estimate the total acid of cider as malic, of wines as tartaric and of beers as acetic. The process of titration is conducted as follows:
Expel any carbon dioxid that is present by continued shaking. Transfer ten cubic centimeters to a beaker and, in the case of white wines, add about ten drops of a neutral litmus solution. Add decinormal sodium hydroxid solution until the red color changes to violet. Then add the reagent, a few drops at a time, until a drop of the liquid, placed on delicate red litmus paper, shows an alkaline reaction.
One cubic centimeter of decinormal sodium hydroxid solution = 0.0075 gram tartaric, 0.0067 of malic and 0.006 gram of acetic acid.
628. Determination of Volatile Acids.—Fifty cubic centimeters of the sample, to which a little tannin has been added to prevent foaming, are distilled in a current of steam. The flask is heated until the liquid boils, when the lamp under it is turned down and the steam passed through until 200 cubic centimeters have been collected in the [Pg 628] receiver. The distillate is titrated with decinormal sodium hydroxid solution and the result expressed as acetic acid.
One cubic centimeter of decinormal sodium hydroxid solution = 0.0060 gram acetic acid.
The acidity due to volatile acids may be determined by ascertaining the total acidity as above described, evaporating 100 cubic centimeters to one-third of their volume, restoring the original volume with water and again titrating. The difference between the first and second titrations represents the volatile acidity.
A method of determining volatile acidity in wines, without the application of heat, has been proposed by de la Source.[641] The sample, five cubic centimeters, freed of carbon dioxid by shaking, is placed in a flat dish about eight centimeters in diameter. In a separate portion of the sample, the total acidity is determined in the presence of phenolphthalien by a set solution of barium hydroxid, one cubic centimeter of which is equal to four milligrams of sulfuric acid. The sample in the flat dish is placed in a desiccator, which contains both sulfuric acid and solid potassium hydroxid, and left for two days, by which time it is practically dry. The residue is dissolved in two cubic centimeters of warm water and the dish is kept in the desiccator for an additional two days. By this time the volatile acids, even acetic, will have disappeared and the residual acidity is determined after solution in water.
The method is also applicable when wines have been treated with an alkali. In this case two samples of five cubic centimeters each are acidified with two cubic centimeters of a solution of tartaric acid containing twenty-five grams per liter. This treatment sets free the volatile acids, and their quantity is determined as before.
629. Titration with Phenolphthalien.—The total acidity is also easily determined by titration with a set alkali, using phenolphthalien as indicator. Colored liquors must be treated with animal black before the analysis. The sample is shaken to expel carbon dioxid and five cubic centimeters added to 100 of water containing phenolphthalien. The [Pg 629] set alkali (tenth normal soda) is added until the red color is discharged. Even wines having a considerable degree of color may be titrated in this way.[642] The acidity, expressed as tartaric, may be stated as due to sulfuric by dividing by 1.53.
630. Determination of Tartaric Acid.—The determination of potassium bitartrate is necessary when an estimation of the free tartaric acid is desired.[643]
Fifty cubic centimeters of wine are placed in a porcelain dish and evaporated to a sirupy consistence, a little quartz sand being added to render subsequent extraction easier. After cooling, seventy cubic centimeters of ninety-six per cent alcohol are added with constant stirring. After standing for twelve hours, at as low a temperature as practicable, the solution is filtered and the precipitate washed with alcohol until the filtrate is no longer acid. The alcoholic filtrate is preserved for the estimation of the tartaric acid. The filter and precipitate are returned to the porcelain dish and repeatedly treated with hot water, each extraction being filtered into a flask or beaker until the washings are neutral. The combined aqueous filtrates and washings are titrated with decinormal sodium hydroxid solution.
One cubic centimeter of decinormal sodium hydroxid solution = 0.0188 gram potassium bitartrate.
The alcoholic filtrate is made up to a definite volume with water and divided into two equal portions. One portion is exactly neutralized with decinormal sodium hydroxid solution, the other portion added, the alcohol evaporated, the residue washed into a porcelain dish and treated as above.
One cubic centimeter decinormal sodium hydroxid solution = 0.0075 gram tartaric acid.
As, however, only half of the free tartaric acid is determined by this method:
One cubic centimeter decinormal sodium hydroxid = 0.0150 gram of tartaric acid.
631. Modified Berthelot-Fleury Method.—Ten cubic centimeters of wine are neutralized with potassium hydroxid solution and mixed in a graduated cylinder with forty cubic centimeters of the same sample. To [Pg 630] one-fifth of the volume, corresponding to ten cubic centimeters of wine, fifty cubic centimeters of a mixture of equal parts of alcohol and ether are added and allowed to stand twenty-four hours. The precipitated potassium bitartrate is separated by filtration, dissolved in water and titrated. The excess of potassium bitartrate over the amount of that constituent present in the wine corresponds to the free tartaric acid.[644]
632. Determination of Tartaric, Malic and Succinic Acids.—Two hundred cubic centimeters of wine are evaporated to one-half, cooled and lead subacetate solution added until the reaction is alkaline.[645] The precipitate is separated by filtration and washed with cold water until the filtrate shows only a slight reaction for lead. The precipitate is washed from the filter into a beaker, by means of hot water, and treated hot with hydrogen sulfid until all the lead is converted into sulfid. It is then filtered hot and the lead sulfid washed with hot water until the washings are no longer acid. The filtrate and washings are evaporated to fifty cubic centimeters and accurately neutralized with potassium hydroxid. An excess of a saturated solution of calcium acetate is added and the liquid allowed to stand from four to six hours with frequent stirring. It is then filtered and the precipitate washed until the filtrate amounts to exactly 100 cubic centimeters. The precipitate of calcium tartrate is converted into calcium oxid by igniting in a platinum crucible. After cooling, from ten to fifteen cubic centimeters of normal hydrochloric acid are added, the solution washed into a beaker and accurately titrated with normal potassium hydroxid solution. Every cubic centimeter of normal acid saturated by the calcium oxid is equivalent to 0.0750 gram tartaric acid. To the amount so obtained, 0.0286 gram must be added, representing the tartaric acid held in solution in the filtrate as calcium tartrate. The sum represents the total tartaric acid in the wine.
The filtrate from the calcium tartrate is evaporated to about twenty-five cubic centimeters, cooled and mixed with three times its volume of ninety-six per cent alcohol. After standing several hours, the precipitate is collected on a weighed filter, dried at 100° and weighed. It represents the calcium salts of malic, succinic and [Pg 631] sulfuric acids and of the tartaric acid which remained in solution. This precipitate is dissolved in a minimum quantity of hydrochloric acid, filtered and the filter washed with hot water. Potassium carbonate solution is added to the hot filtrate, and the precipitated calcium carbonate separated by filtration and washed. The filtrate contains the potassium salts of the above named acids. It is neutralized with acetic acid, evaporated to a small volume and precipitated hot with barium chlorid. The precipitate of barium succinate and sulfate is separated by filtration, washed with hot water and treated on the filter with dilute hydrochloric acid. The barium sulfate remaining is washed, dried, ignited and weighed. In the filtrate, which contains the barium succinate, the barium is precipitated hot with sulfuric acid, washed, dried, ignited and weighed. Two hundred and twenty-three parts of barium sulfate equal 118 parts of succinic acid. The succinic and sulfuric acids, as well as the tartaric acid remaining in solution, which is equal to 0.0286 gram, are to be calculated as calcium salts and the result deducted from the total weight of the calcium precipitate. The remainder is the calcium malate, of which 172 parts equal 134 parts malic acid.
According to Macagno, succinic acid may be estimated in wines by the following process:[646] One liter of the wine is digested with lead hydroxid, evaporated on the water bath and the residue extracted with strong alcohol. The residual salts of lead are boiled with a ten per cent solution of ammonium nitrate, which dissolves the salts of succinic acid. The solution is filtered, the lead removed by hydrogen sulfid, boiled, neutralized with ammonia and treated with ferric chlorid as long as a precipitate is formed. The ferric succinate is separated by filtration, washed and ignited. The succinic acid is calculated from the weight of ferric oxid obtained.
Malic acid in wines and ciders is determined by the method of Berthelot in the following manner:[647] The sample is evaporated until reduced to a tenth of its volume. To the residue an equal volume of ninety per cent alcohol is added and the mixture set aside for some time. The tartaric acid and tartrates separate, together with the greater part of the salts of lime which may be present. [Pg 632]
The supernatant liquid is decanted and a small quantity of lime added to it until in slight excess of that required to neutralize the acidity. Calcium malate is separated mixed with lime. The solid matters are separated by filtration, dissolved in a ten per cent solution of nitric acid, from which the lime bimalate will separate in a crystalline form. The weight of calcium bimalate multiplied by 0.59 gives that of the malic acid.
633. Polarizing Bodies in Fermented Beverages.—The study of the nature of the carbohydrates, which constitute an important part of the solid matters dissolved in fermented beverages, is of the greatest importance. These bodies consist of grape sugars, sucrose, tartaric acid and the unfermented hydrolytic products derived from starch. A natural grape sugar (chiefly dextrose) is found in wines. Sucrose is also a very important constituent of sweet wines. The hydrolytic products of starch are found in beers, either as a residue from the fermentation of malt or from the rice, glucose, hominy grits etc., added in brewing. The character and quantities of these residues can be determined by the methods already given in the parts of this volume relating to sugars and starches. For convenience, however, and for special application to the investigation of fermented beverages a résumé of the methods adopted by the official chemists follows:[648]
634. Determination of Reducing Sugars.—The reducing sugars are estimated as dextrose, and may be determined by any of the methods given for the estimation thereof (113-140).
635. Polarization.—All results are to be stated as the polarization of the undiluted sample. The triple field shadow saccharimeter is recommended, and the results are expressed in the terms of the sugar scale of this instrument. If any other instrument be used, or if it be desirable to convert to angular rotation, the following factors may be employed:
| 1° Schmidt and Haensch | = 0°.3468 | angular rotation D. |
| 1° angular rotation D | = 2°.8835 | Schmidt and Haensch. |
| 1° Schmidt and Haensch | = 2°.6048 | Wild (sugar scale). |
| 1° Wild (sugar scale) | = 0°.3840 | Schmidt and Haensch. |
| 1° Wild (sugar scale) | = 0°.1331 | angular rotation D. |
| 1° angular rotation D | = 0°.7511 | Wild (sugar scale). |
| 1° Laurent (sugar scale) | = 0°.2167 | angular rotation D. |
| 1° angular rotation D | = 4°.6154 | Laurent (sugar scale). |
[Pg 633] In the above table D represents the angular rotation produced with yellow monochromatic light.
(a) In White Wines or Beers.—Sixty cubic centimeters of wine are decolorized with three cubic centimeters of lead subacetate solution and filtered. Thirty cubic centimeters of the filtrate are treated with one and five-tenths cubic centimeters of a saturated solution of sodium carbonate, filtered and polarized. This gives a solution of nearly ten to eleven, which must be considered in the calculation, and the polariscope reading must accordingly be increased one-tenth.
(b) In Red Wines.—Sixty cubic centimeters of wine are decolorized with six cubic centimeters of lead subacetate solution and filtered. To thirty cubic centimeters of the filtrate, three cubic centimeters of a saturated solution of sodium carbonate are added, filtered and the filtrate polarized. The dilution in this case is nearly five to six, and the polariscope reading must accordingly be increased one-fifth.
(c) In Sweet Wines. (1) Before Inversion.—One hundred cubic centimeters are decolorized with two cubic centimeters of lead subacetate solution and filtered after the addition of eight cubic centimeters of water. One-half cubic centimeter of a saturated solution of sodium carbonate and four and five-tenths cubic centimeters of water are added to fifty-five cubic centimeters of the filtrate, the liquids mixed, filtered and polarized. The polariscope reading is multiplied by 1.2.
(2) After Inversion.—Thirty-three cubic centimeters of the filtrate from the lead subacetate in (1) are placed in a flask with three cubic centimeters of strong hydrochloric acid. After mixing well, the flask is placed in water and heated until a thermometer, placed in the flask with the bulb as near the center of the liquid as possible, marks 68°, consuming about fifteen minutes in the heating. It is then removed, cooled quickly to room temperature, filtered and polarized, the temperature being noted. The polariscope reading is multiplied by 1.2. Because of the action of lead subacetate on invert sugar (87) it is advisable to decolorize the samples with other reagents (87-89).
(3) After Fermentation.—Fifty cubic centimeters of wine, which [Pg 634] have been dealcoholized by evaporation and made up to the original volume with water, are mixed, in a small flask, with well washed beer yeast and kept at 30° until fermentation has ceased, which requires from two to three days. The liquid is washed into a 100 cubic centimeter flask, a few drops of a solution of acid mercuric nitrate and then lead subacetate solution, followed by sodium carbonate, added. The flask is filled to the mark with water, shaken, the solution filtered and polarized and the reading multiplied by two.
636. Application of Analytical Methods.—(1) There is no rotation.—This may be due to the absence of any rotatory body, to the simultaneous presence of the dextrorotatory nonfermentable constituents of commercial dextrose and levorotatory sugar, or to the simultaneous presence of dextrorotatory cane sugar and levorotatory invert sugar.
(a) The Wine is Inverted.—A levorotation shows that the sample contains cane sugar.
(b) The Wine is Fermented.—A dextrorotation shows that both levorotatory sugar and the unfermentable constituents of commercial dextrose are present.
If no change take place in either (a) or (b) in the rotation, it proves the absence of unfermented cane sugar, the unfermentable constituents of commercial dextrose and of levorotatory sugar.
(2) There is right rotation.—This may be caused by unfermented cane sugar, the unfermentable constituents of commercial dextrose or both.
(a) The sugar is inverted:
(a₁) It rotates to the left after inversion.—Unfermented cane sugar is present.
(a₂) It rotates more than 2°.3 to the right.—The unfermentable constituents of commercial dextrose are present.
(a₃) It rotates less than 2°.3 and more than 0°.9 to the right.—It is in this case treated as follows:
Two hundred and ten cubic centimeters of the sample are evaporated to a thin sirup with a few drops of a twenty per cent solution of potassium acetate. To the residue 200 cubic centimeters of ninety per cent alcohol are added with constant stirring. The alcoholic solution is [Pg 635] filtered into a flask and the alcohol removed by distillation until about five cubic centimeters remain. The residue is mixed with washed bone-black, filtered into a graduated cylinder and washed until the filtrate amounts to thirty cubic centimeters. When the filtrate shows a dextrorotation of more than 1°.5, it indicates the presence of unfermentable constituents of commercial dextrose.
(3) There is left rotation.—The sample contains unfermented levorotatory sugar, derived either from the must or mash or from the inversion of added cane sugar. It may, however, also contain unfermented cane sugar and the unfermentable constituents of commercial dextrose.
(a) The wine sugars are fermented according to directions in 262.
(a₁) It polarizes 3° after fermentation.—It contains only levorotatory sugar.
(a₂) It rotates to the right.— It contains both levorotatory sugar and the unfermentable constituents of commercial dextrose.
(b₁) The sucrose is inverted according to (c), in (2).
(b₂) It is more strongly levorotatory after inversion. In contains both levorotatory sugar and unfermented cane sugar.
637. Estimation of Sucrose, Dextrose, Invert Sugar, Maltose and Dextrin.—The total and relative quantities of these carbohydrates are determined by the processes already described (237-262).
638. Determination of Glycerol.—(a) In Dry Wines and Beers.—One hundred cubic centimeters of wine are evaporated in a porcelain dish to about ten cubic centimeters, a little quartz sand and milk of lime added and the evaporation carried almost to dryness. The residue is mixed with fifty cubic centimeters of ninety per cent alcohol, using a glass pestle or spatula to break up any solid particles, heated to boiling on the water bath, allowed to settle and the liquid filtered into a small flask. The residue is repeatedly extracted in a similar manner, with small portions of boiling alcohol, until the filtrate in the flask amounts to about 150 cubic centimeters. A little quartz sand is added, the flask connected with a condenser and [Pg 636] the alcohol slowly distilled until about ten cubic centimeters remain. The evaporation is continued on the water bath until the residue becomes sirupy. It is cooled and dissolved in ten cubic centimeters of absolute alcohol. The solution may be facilitated by gentle heating on the steam bath. Fifteen cubic centimeters of anhydrous ether are added, the flask stoppered and allowed to stand until the precipitate has collected on the sides and bottom of the flask. The clear liquid is decanted into a tared weighing bottle, the precipitate repeatedly washed with a few cubic centimeters of a mixture of one part of absolute alcohol and one and five-tenths parts anhydrous ether and the washings added to the solution. The ether-alcohol is evaporated on the steam bath, the residue dried one hour in a water oven, weighed, the amount of ash determined and its weight deducted from that of the weighed residue to get the quantity of glycerol.
(b) In Sweet Wines.—One hundred cubic centimeters of wine are evaporated on the steam bath to a sirupy consistence, a little quartz sand being added to render subsequent extraction easier. The residue is repeatedly treated with absolute alcohol until the united extracts amount to from 100 to 150 cubic centimeters. The solution is collected in a flask and for every part of alcohol one and five-tenths parts of ether are added, the liquid well shaken and allowed to stand until it becomes clear. The supernatant liquor is decanted into a beaker and the precipitate washed with a few cubic centimeters of a mixture of one part alcohol and one and five-tenths parts ether. The united liquids are distilled, the evaporation being finished on the water bath, the residue is dissolved in water, transferred to a porcelain dish and treated as under (a).
639. Determination of Coloring Matters in Wines.—The methods of detecting the more commonly occurring coloring matters in wines as practiced by the official chemists are given below.
(a) Cazeneuve Reaction.—Add two-tenths gram of precipitated mercuric oxid to ten cubic centimeters of wine, shake for one minute and filter.
Pure wines give filtrates which are colorless or light yellow, while the presence of a more or less red coloration indicates that an anilin color has been added to the wine. [Pg 637]
(b) Method of Sostegni and Carpentieri.—Evaporate the alcohol from 200 cubic centimeters of wine. Add from two to four cubic centimeters of a ten per cent solution of hyrochloric acid, immerse therein some threads of fat-free wool and boil for five minutes. Remove the threads, wash them with cold water acidified with hydrochloric, then with hot water acidified with hydrochloric, then with pure water and dissolve the color in a boiling mixture of fifty cubic centimeters of water and two cubic centimeters of concentrated ammonia. Replace the threads by new ones, acidify with hydrochloric and boil again for five minutes. In the presence of anilin colors to the amount of two milligrams per liter, the threads are dyed as follows:
| Safranin | light rose-red. |
| Vinolin | rose-red to violet. |
| Bordeaux-red | rose-red to violet. |
| Ponceau-red | rose-red. |
| Tropæolin oo | straw yellow. |
| Tropæolin ooo | light orange. |
(c) Detection of Fuchsin and Orseille.—To twenty cubic centimeters of wine add ten cubic centimeters of lead acetate solution, heat slightly and mix by shaking. Filter into a test-tube, add two cubic centimeters of amyl alcohol and shake. If the amyl alcohol be colored red, separate it and divide it into two portions. To one add hydrochloric acid, to the other ammonia. When the color is due to fuchsin, the amyl alcohol will in both cases be decolorized; when due to orseille, the ammonia will change the color of the amyl alcohol to purple-violet.
640. Determination of Ash.—The residue from the direct extract determination is incinerated at as low a heat as possible. Repeated moistening, drying and heating to low redness is advisable to get rid of all organic substances. When a quantitive analysis of the ash is desired, large quantities of the sample are evaporated to dryness and the residue incinerated with the usual precautions.
641. Determination Of Potash.—(a) Kayser’s Method.—Dissolve seven-tenths gram pure sodium hydroxid and two grams of tartaric acid in 100 cubic centimeters of wine, add 150 cubic [Pg 638] centimeters of ninety-two to ninety-four per cent alcohol and allow the liquid to stand twenty-four hours. The precipitated potassium bitartrate is collected on a small filter and washed with fifty per cent alcohol until the filtrate amounts to 260 cubic centimeters. The precipitate and filter are transferred to the beaker in which the precipitation was made, the precipitate dissolved in hot water, the volume made up to 200 cubic centimeters and fifty cubic centimeters thereof titrated with decinormal sodium hydroxid solution, adding 0.004 gram to the final result, representing the potash which remains in solution as bitartrate.
(b) Platinum Chlorid Method.—Evaporate 100 cubic centimeters of the wine to dryness, incinerate the residue and determine the potash as in ash analysis.[649]
642. Determination of Sulfurous Acid.—One hundred cubic centimeters of wine are distilled in a current of carbon dioxid, after the addition of phosphoric acid, until about fifty cubic centimeters have passed over. The distillate is collected in accurately set iodin solution. When the distillation is finished, the excess of iodin is determined with set sodium thiosulfate solution and the sulfurous acid calculated from the iodin used.
643. Detection of Salicylic Acid.—(a) Spica’s Method.—Acidify 100 cubic centimeters of the liquor with sulfuric and extract with sulfuric ether. Evaporate the extract to dryness, warm the residue carefully with one drop of concentrated nitric acid and add two or three drops of ammonia. The presence of salicylic acid in the liquor is indicated by the formation of a yellow color due to ammonium picrate and may be confirmed by dyeing therein a thread of fat-free wool.
(b) Bigelow’s Method.—Place 100 cubic centimeters of the wine in a separatory funnel, add five cubic centimeters of sulfuric acid (1-3) and extract with a sufficient quantity of a mixture of eight or nine parts of ether to one part of petroleum ether. Throw away the aqueous part of the extract, wash the ether once with water, then shake thoroughly with about fifty cubic centimeters of water, to which from [Pg 639] six to eight drops of a one-half per cent solution of ferric chlorid have been added. Discard the aqueous solution, which contains the greater part of the tannin in combination with iron, wash again with water, transfer the ethereal solution to a porcelain dish and allow to evaporate spontaneously. Heat the dish on the steam bath, take up the residue with one or two cubic centimeters of water, filter into a test-tube and add one to two drops of one-half per cent solution of ferric chlorid. The presence of salicylic acid is indicated by the appearance of a violet-red coloration. In the case of red wines, a second extraction of the residue with ether mixture is sometimes necessary. This method cannot be used in the examination of beers and ales.
(c) Girard’s Method.—Extract a portion of the acidified liquor with ether as in the preceding methods, evaporate the extract to dryness and exhaust the residue with petroleum ether. The residue from the petroleum ether extract is dissolved in water and treated with a few drops of a very dilute solution of ferric chlorid. The presence of salicylic acid is indicated by the appearance of a violet-red coloration.
644. Detection of Gum and Dextrin.—Four cubic centimeters of the sample are mixed with ten cubic centimeters of ninety-six per cent alcohol. When gum arabic or dextrin is present, a lumpy, thick and stringy precipitate is produced, whereas pure wine becomes at first opalescent and then gives a flocculent precipitate.
645. Determination of Nitrogen.—The best method of determining nitrogen in fermented beverages is the common one of moist combustion with sulfuric acid. The sample is placed in the kjeldahl digestion flask, which is attached to the vacuum service and placed in a steam bath until its contents are dry or nearly so. The process is then conducted in harmony with the well known methods. Where large quantities of the sample are to be employed, as in drinks containing but little nitrogen, the preliminary evaporation may be accomplished in an open dish, the contents of which are transferred to the digestion flask before any solid matter is deposited. The same procedure may be followed when the sample foams too much on heating. [Pg 640]
646. Substitutes for Hops.—It is often claimed that cheap and deleterious bitters are used in brewing in order to save hops. While it is doubtless true that foreign bitters are sometimes employed, the experience of this laboratory goes to show that such an adulteration is not very prevalent in this country.[650] Possibly strychnin, picrotoxin, quassin, gentian and other bitter principles have sometimes been found in beer, but their use is no longer common. It is difficult to decide in every case whether or not foreign bitters have been added. A common process is to treat the sample with lead acetate, filter, remove the lead from the filtrate and detect any remaining bitters by the taste. All the hop bitters are removed by the above process. Any remaining bitter taste is due to other substances. For the methods of detecting the special bitter principles in hops and other substances, the work of Dragendorff may be consulted.[651]
647. Bouquet of Fermented and Distilled Liquors.—The bouquet of fermented and distilled liquors is due to the presence of volatile matters which may have three different origins. In the first place the materials from which these beverages are made contain essential oils and other odoriferous principles.[652] In the grape, for instance, the essential oils are found particularly in the skins. These essential principles may be secured by distilling the skins of grapes in a current of steam. This method of separation, however, cannot be regarded as strictly quantitive.
In the second place, the yeasts which produce the alcoholic fermentation are also capable of producing odoriferous products. These minute vegetations, resembling in their biological relations the mushrooms, grow in the soil and reach their maturity at about the time of the harvest of the grapes. Their spores are transmitted through the air, reach the expressed grape juice and produce the vinous fermentation. The particular odor due to any given yeast persists through many generations of culture showing that the body which produces the odor is the direct result of the vegetable activity of the yeast. A beer yeast, after many generations of culture, will still give a product which smells like beer, and in like manner a wine yeast will produce one which has the odor of wine. The quantity of odorant matter [Pg 641] produced by this vegetable action is so minute as to escape detection in a quantitive or qualitive way by chemical means. These subtle perfumes arise moreover not only from the breaking up of the sugar molecule, but are also the direct results of molecular synthesis accomplished under the influence of the yeast itself.
In the third place, the fermented and distilled liquors contain odoriferous principles due to the chemical reactions which take place by the breaking up of the sugar and other molecules during the process of fermentation. The alcohols and acids produced have distinct odors by which they are often recognized. This is particularly true of ethylic, propylic, butylic, amylic and oenanthylic alcohols and acetic acid. These alcohols themselves also undergo oxidation, passing first into the state of aldehyds which, together with ethers, produce the peculiar aroma which is found in various fruits. The etherification noted above is of course preceded by the formation of acids corresponding to the various aldehyds present. The formation of these ethers takes place very slowly during aging, and it therefore requires three or four years for the proper ripening of wines or distilled liquors. By means of artificial heat, electricity and aeration, the oxidizing processes above noted may be hastened, but it is doubtful whether the products arising from this artificial treatment are as perfect as those which are formed in the natural processes.
[535] Bulletin 46, Chemical Division U. S. Department of Agriculture, pp. 24-25.
[536] Bulletin 42, Arkansas Agricultural Experiment Station, pp. 81 et seq.
[537] Balland; Recherches sur les Blés, les Farines et le Pain, p. 229.
[538] Jago; Flour and Bread, p. 457.
[539] Jago; op. cit. supra, p. 465.
[540] Richardson; Journal of the Chemical Society, Transactions, 1885, pp. 84 et seq.
[541] Auct. et op. cit. supra, pp. 80 et seq.
[542] Bulletin 28, Office of Experiment Stations, U. S. Department of Agriculture, pp. 9, 10.
[543] Bulletin 29, Office of Experiment Stations U. S. Department of Agriculture, p. 8.
[544] Op. et. loc. cit. supra.
[545] Experiment Station Record, Vol. 6, pp. 590 et seq.
[546] Annual Report, U. S. Department of Agriculture, 1884, p. 365.
[547] Forschungs-Berichte über Lebensmittel, Band 3, S. 142.
[548] Zeitschrift für angewandte Chemie, 1895, S. 620.
[549] Op. et loc. cit. supra.
[550] Les Ferments Solubles; Diastases—Enzymes.
[551] Wiley; Medical News, July, 1888.
[552] Virchow’s Archiv., Band 123, S. 230: Journal of the Chemical Society, Abstracts, 1892, p. 755.
[553] Ladenberg; Handwörterbuch der Chemie, Band 4, S. 122.
[554] Chemisches Centralblatt, 1892, Band 2, S. 579.
[555] Op. cit. supra, 1890, Band 2, S. 628.
[556] Die Landwirtschaftlichen Versuchs-Stationen, Band 44, S. 188; Experiment Station Record, Vol. 6, p. 12.
[557] Experiment Station Record, Vol. 6, pp. 5 et seq. (Read Jordan instead of Gordon.)
[558] Journal of the American Chemical Society, Vol. 16, pp. 590 et seq.
[559] From photograph made in this laboratory by Bigelow.
[560] Journal of the Society of Chemical Industry, Vol. 10, p. 118.
[561] Die Landwirtschaftlichen Versuchs-Stationen, Band 36, S. 321: Bulletin 13, Chemical Division, U. S. Department of Agriculture, p. 1028.
[562] Wilson; Vid. op. et loc. cit. 26.
[563] U. S. Dispensatory, p. 1088.
[564] Landwirtschaftliche Jahrbücher, 1890, Band 19, S. 149.
[565] Bulletin 13, Chemical Division, U.S. Department of Agriculture, p. 1028.
[566] Zeitschrift für analytische Chemie, Band 35, S. 498.
[567] Annual Report of the Maine Agricultural Experiment Station, 1891, p. 25: Gay; Annales Agronomiques, 1885, p. 145, et 1896, pp. 145 et seq.
[568] Annales Agronomiques, Tome 21, pp. 149, 150.
[569] Vid. op. et loc. cit. primo sub 33.
[570] Twelfth Annual Report of the Massachusetts Agricultural Experiment Station, 1894, p. 175.
[572] Manuscript prepared for publication as a part of Bulletin 13, Chemical Division, U. S. Department of Agriculture.
[574] Vid. op. cit. 31, p. 1020.
[575] Bulletin 45, Chemical Division, U.S. Department of Agriculture, p. 12.
[576] Berthelot; Essai de Chimie Mécanique: Thomsen; Thermo Chemische Untersuchungen: Ostwald; Algemeine Chemie: Muir; Elements of Thermal Chemistry.
[577] Bulletin 21, Office of Experiment Stations, U. S. Department of Agriculture, pp. 113 et seq.: Seventh Annual Report Connecticut (Storr’s) Agricultural Experiment Station, pp. 133 et seq.
[578] Vid. op. et loc. cit. 43.
[579] From personal inspection by author in Williams’ laboratory, 161 Tremont St., Boston, Mass.
[580] Journal für praktische Chemie, Band 147 {Neue Folge Band 39}, Ss. 517 et seq.
[581] Berthelot; Annales de Chemie et de Physique, 6e Série, Tome 10, p. 439.
[582] Vid. op. cit. 46, Ss. 522-523. The data in paragraph 566 are taken from Stohmann, Zeitschrift für Biologie, Band 31, S. 364 and Experiment Station Record, Vol. 6, p. 590.
[583] Journal of the American Chemical Society, Vol. 18, p. 174.
[584] Bulletins 93, 97, 101 and 102, California Agricultural Experiment Station.
[585] Annual Report, U. S. Department of Agriculture, 1886, p. 354.
[586] This work, Vol. 2, p. 318.
[587] Vid. California Bulletins cited under 50: Wolff; Aschen Analyse, S. 126.
[588] Bulletin 100, Cornell Agricultural Experiment Station: Bulletin 48, Chemical Division, U. S. Department of Agriculture.
[589] Vid. op. cit. 51, p. 353.
[590] Vid. op. cit. ultimo sub 54.
[591] Bulletin No. 42, Arkansas Agricultural Experiment Station, p. 78.
[592] Annual Report, U. S. Department of Agriculture, 1884, p. 347.
[593] Spencer; Bulletin 13, U. S. Department of Agriculture, pp. 875 et seq.
[594] Journal of Analytical and Applied Chemistry, Vol. 4, p. 390; Bulletin 13, Chemical Division, U. S. Department of Agriculture, p. 889.
[595] Pharmaceutical Journal, Vol. 52, p. 213.
[596] Commercial Organic Analysis, Vol. 3, part 2, p. 484.
[597] Journal de Pharmacie et de Chimie, 6ᵉ Série, Tome 3, p. 529.
[598] Journal of the American Chemical Society, Vol. 18, p. 338.
[599] Manuscript communication to author.
[600] Vid. op. cit. 63, p. 533.
[601] American Chemical Journal, Vol. 14, p. 473.
[602] Op. et loc. cit. supra.
[603] Lindsey; Report made to Thirteenth Annual Convention of the Association of Official Agricultural Chemists, Nov. 6th, 1896: Tollens; Handbuch der Kohlenhydrate, Band 2, S. 52.
[604] Zeitschrift für angewandte Chemie, 1896, p. 195,
[605] Comptes rendus hebdomadaires de Seances de l’Academie des Sciences, Tome 122, p. 841.
[606] The Tannins, two volumes.
[607] Dragendorff; Plant Analysis.
[608] The Tannins, Vol. 1, p. 33.
[609] Bulletin 13, Chemical Division, U. S. Department of Agriculture, p. 908.
[610] Vid. op. cit. 74, p. 38.
[611] Bulletin 46, Chemical Division, U. S. Department of Agriculture, p. 77 as revised at 13th annual meeting of the Association of Official Agricultural Chemists.
[612] Vid. op. cit. 75, p. 890: Zeitschrift für analytische Chemie, Band 25, S. 121: Journal of the Society of Chemical Industry, Vol. 3, p. 82: Trimble; The Tannins, Vol. 1, p. 44.
[613] Vid. op. cit. 74, p. 48.
[614] McElroy; Analyses made in this laboratory.
[615] Annual Report Connecticut Agricultural Experiment Station (New Haven) 1892, p. 30.
[616] Kissling; Tabakkunde, S. 40.
[617] Vid. op. cit. supra, S. 58.
[618] Vid. op. cit. 81, p. 29.
[619] This work, Vol 1, pp. 500 et seq.
[620] This work, Vol. 1, p. 420.
[621] Vid. op. cit. 82, S. 62.
[622] Vid. op. cit. supra, S. 64.
[623] Dragendorff; Plant Analysis, p. 65.
[624] Sugar, 1896, March 15th, p. 11.
[625] Vid. op. cit. 82, S. 65.
[626] Der Tabak, S. 144.
[627] Vid. op. cit. 82, S. 65: Zeitschrift für analytische Chemie, Band 21, S. 76: Band 22, S. 199: Band 32, S. 277: Band 34, Ss. 413-731.
[628] Zeitschrift für physiologische Chemie Band 13, S. 445: Band 14, S. 182.
[629] Zeitschrift für analytische Chemie, Band 34, S. 413, Band 35, Ss. 309, 731.
[630] Annual Report Connecticut Agricultural Experiment Station (New Haven), 1892, p. 17.
[631] Buell; The Cider-makers’ Manual: Southby; Systematic Text-Book of Practical Brewing: Moritz and Morris; Text-Book of the Science of Brewing.
[632] Gautier; Sophistication et Analyse des Vins, p. 49.
[633] Auct. et. op. cit. supra, p. 44.
[634] Bulletin 46, Chemical Division, U. S. Department of Agriculture, p. 63.
[635] Manuscript not yet published.
[636] Vid. op. cit. 100, pp. 95 et seq.
[637] Wiley; Journal of the American Chemical Society, Vol. 18, p. 1063.
[638] Vid. op. cit. 100, p. 70.
[639] Vid. op. cit. 98, p. 65.
[640] Vid. op. cit. 98, p. 67.
[641] The Analyst, Vol. 21, p. 158.
[642] Vid. op. cit. 98, p. 98.
[643] Vid. op. cit. 100, p. 74.
[644] Vid. op. cit. 100, p. 75.
[645] Vid. op. cit. 100, p. 75.
[646] Bulletin de la Société Chimique de Paris, Série {2}, Tome 24, p. 288; Berichte der deutschen chemischen Gesellschaft, Band 8, S. 257.
[647] Vid. op. cit. 98, p. 120.
[648] Bulletin 46, Chemical Division U. S. Department of Agriculture, pp. 72, et. seq.
[649] This work, Vol. 2, pp. 267 and 326.
[650] Bulletin 13, Chemical Division, U. S. Department of Agriculture, p. 296.
[651] Plant Analysis, pp. 38, et seq.
[652] Repertoire de Pharmacie, Série 3e, Tome 7, p. 436.
Page 5, 11th line, insert “ten” before “thousand.”
Page 21, read “Magdeburg” instead of “Madgeburg” in both instances.
Page 61, for per cent. of oxygen in ulmin read “28.7” instead of “8.7.”
Page 62, for per cent. of carbon in apocrenic acid read “54.4” instead of “34.4.”
Page 112, 2d line from bottom, read “14” instead of “13.”
Page 140, the sentence beginning “The burette is lowered etc.” is repeated. Dele one of them.
Page 141, 6th line, insert “or air dried” after “moisture.”
Page 141, in example read 10.25, 10.22, 13.07 and 76.21 for 9.52, 9.22, 12.07, and 60.35 respectively.
Page 158, 3d line of 172, insert “and estimating soluble matters therein” after “flow.”
Page 159, omit “√ ” in first formula.
Page 293, 12th line, read “U” for “V.”
Page 309, last line, read “sixth” for “sixteenth.”
Page 312, 1st line, read “atmosphere” instead of “room.”
Page 315, 6th and 7th lines, read 299, and 300, for 294, and 295, respectively.
Page 323, 3d line from bottom, read 301 for 299.
Page 333, 5th line of 316, insert after “is” “to eliminate carbon dioxid and.”
Page 354, 3d line from end of (6) insert after “solution” “acidified with acetic and;” same line, transfer “r” from “ther,” to “pecipitate.”
Page 357, 6th line from end of (4) insert after “difference” “and the phosphoric acid estimated as in 380, deducted therefrom.”
Page 367, 4th line, add after “taken,” “The phosphoric acid may be determined as described in 372, or following paragraphs.”
Page 410, line 21, dele “dilute” and insert “one per cent nitric.”
Page 410, line 25, after “capsule” insert “adding water once or twice.”
Page 449, 4th line read “hydrobromic” for “hydrochloric.”
Page 457, reference “30” read “Band 38” instead of “Band 37.”
Page 468, 8th line, dele “or gypsum” and read “200” instead of “50.”
Page 471, last line, read “not” for “very.”
Page 472, 4th line, insert “un” before “successful.”
Page 496, 5th line, insert “the” before “soil.”
Page 515, next to last and last lines, read “stannous” instead of “zinc.”
Page 516, second line, read “stannous” instead of “zinc.”
Page 557, 9th line of 500 read “red-yellow” instead of “blue.”
Page 14, line 21, read “61.74 per cent.” for “16.74 per cent.”
Page 23, 8th line from bottom, read “0.0025.” for “0.0035.”
Page 54, 9th line, read “white” instead of “yellow.”
Page 54, 13th line, read “phosphate” instead of “phosphomolybdate.” [Pg 667]
Page 57, 8th line from bottom, read “saturated” instead of “citrate.”
Page 73, read “Kosmann” in 10th line of paragraph 72 for “Kormann.”
Page 158, reference number 72, read “1889” instead of “1888.”
Page 11, name of Figure 4 read “Dreef” instead of “Dree.”
Page 40, fifth and seventh lines, read “Courtonne” instead of “Courtoune.”
Page 59, eighth line from bottom, insert “original” before “optical.”
Page 60, second line, read “d” instead of “l” before “fructose.”
Page 68, legend of Figure 29, read “areometers” instead of “aereometers.”
Page 146, sixth line from bottom, insert “cyanid” after “potassium.”
Page 159, instead of headings for table as given, substitute those on page 160.
Page 177, in formula for lactose, read “H₂₂” instead of “H₃₂”; in formula for arabinose, read “H₁₀” instead of “H₁₉.”
Page 180, seventh line from bottom, read “Günther” instead of “Gunther.”
Page 191, read paragraph 169. Seventh line read “resorcin” instead of “resorsin.”
Page 268, legend of Figure 77, read “Desiccating” instead of “Dessicating.”
Page 288, in formula (2) read “53d” instead of “54d.”
Pages 328, 329 and 334, read “Amagat” instead of “Armagat.”
Page 348, fourth line from bottom, omit accent in “sesame.”
Page 365, (b) first line, read 24.8 instead of 24.6.
Page 424, 4th line from bottom, read “nitrites” instead of “nitrates.”
Page 425, 4th and 5th lines, read “nitrite” instead of “nitrate.”
Page 445, in table of factors for computing proteids under Maize Proteids, read “16.06 and 6.22” instead of “15.64 and 6.39” respectively.
Page 451, sixth line from bottom, read “occur” instead of “occurs.”
Page 464, twelfth line from bottom, dele “food.”
Page 499, ninth line from bottom, read “Babcock.”
Page 543, sixteenth line, read “6.06 and 6.22” for “6.31 and 6.39” respectively.
Pages 555-556, read “amylolytic” for “amylytic.”
Page 555, fifth and seventeenth lines from bottom, insert after “into dextrin, maltose.”
Page 572, second equation, read “tʹₙ₂” instead of “tʹₙ₁.”
Page 573, 3rd line from bottom, read “stirring” for “storing.”
Page 574, 6th line from bottom, read “Θ₄” for “O_4.”
Page 575, 16th line from bottom, insert “one gram of” before “substance.”
Page 576 instead of 567, fourth line of paragraph 566, read “Calorie” instead of “calorie.”
Page 644, dele “Band 12, Ss. 64 und 199” in reference 94.
Transcriber’s Notes:
The cover image was created by the transcriber, and is in the public domain.
New original cover art included with this eBook is granted to the public domain.
Deprecated spellings were not corrected.
The illustrations have been moved so that they do not break up paragraphs and so that they are next to the text they illustrate.
Typographical and punctuation errors have been silently corrected.